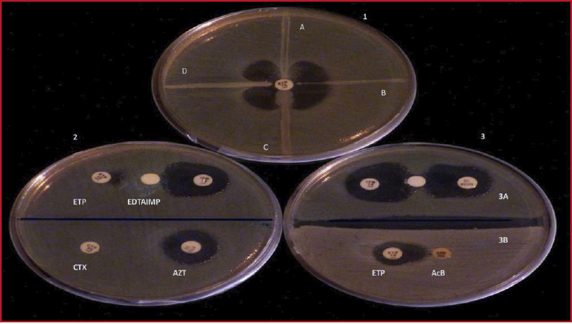
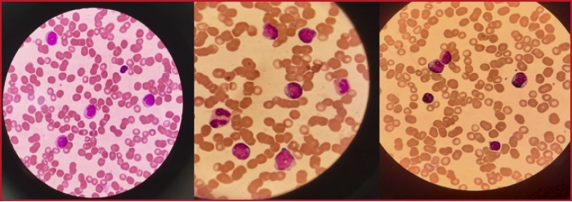
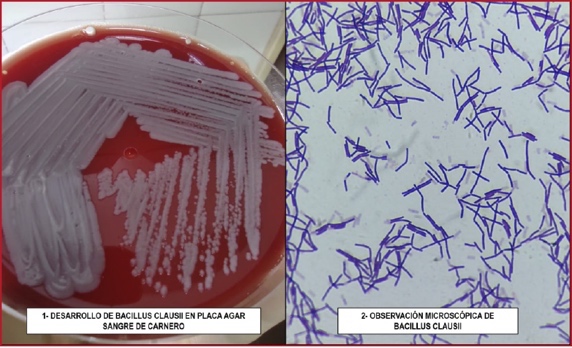

Suplemento 1 - Año
2022
RESÚMENES
32º Congreso Argentino e Internacional de Terapia Intensiva
9 al 11 de noviembre de 2022
“Tiempo de reencuentro y gestión de cambios”
25º Congreso Argentino de Enfermería en Terapia Intensiva
24º Congreso
Argentino de Kinesiología en Terapia Intensiva
23º Congreso
Argentino de Terapia Intensiva Pediátrica
18º Jornada
Nacional de Bioquímicos en Terapia Intensiva
15º Jornada del
Comité de Neonatología Critica
9º Jornada de
Farmacéuticos en Terapia Intensiva
9º Jornada de
Lics. en Nutrición en Terapia Intensiva
9º Jornada de
Veterinaria en Terapia Intensiva
SOCIEDAD
ARGENTINA DE TERAPIA INTENSIVA
COMISIÓN DIRECTIVA (2021-2023)
Presidente
Guillermo Ricardo Chiappero
Vicepresidenta
María Cristina Orlandi
Secretario
Fernando Gabriel Ríos
Prosecretaria
Mónica Viviana Romero
Tesorera
Susana Beatriz Bauque
Protesorero
Marcelo Fabio Morales
Directora de Publicaciones
Analía Fernández
Directora de Departamento Docencia
Adelina Badolatti
Vocales Titulares
Cecilia Mariana Torre
Gustavo Adolfo Benavent
Daniela Olmos Kutscherauer
Natalia Llanos
Jorge Marcelo Prochasko
Alejandro Javier Siaba Serrate
Alejandro Miguel Risso Vázquez
Judith Isabel Sagardía
Vocales Suplentes
Carlos Stoltzing
Leandro Ismael Tumino
Carina Fernanda Tolosa
Héctor José María Alvarez
Mariela Alejandra Velásquez
Norberto Cristian Pozo
Graciela Elizabeth Aguilera
Mariela Allassia
Revisores de Cuentas Titulares
Cecilia Inés Loudet
Mónica Isabel Quinteros
Héctor Antonio Ferraro
Revisores de Cuentas Suplentes
Ernesto Fabián Rodríguez
Silvina Carina Balasini
EX-PRESIDENTES
1972-1973:
Aquiles Roncoroni
1973-1975:
Miguel Herrera
1975-1976:
Juan Carlos Figueroa Casas
1976-1977:
Ernesto Maña
1977-1979:
Héctor De Leone
1979-1980:
José Petrolito
1980-1982:
Roberto Apra
1982-1983:
Roberto Padrón
1983-1985:
Gustavo Marino Aguirre
1985-1987:
Antonio Gallesio
1987-1989:
Carlos Lovesio
1989-1991:
Juan Pacin
1991-1993:
Mario Santamarina
1993-1995:
Fernando Pálizas
1995-1997:
Roberto Bastianelli
1997-1999:
Jorge Neira
1999-2001:
José L. do Pico
2001-2003:
Daniel Ceraso
2003-2005:
Francisco José Criado
2005-2007:
Eduardo San Román
2008-2009:
Elisa Estenssoro
2009-2011:
Ignacio Previgliano
2011-2013:
Cayetano Guillermo Galletti
2013-2015:
Néstor Omar Raimondi
2015-2017:
Rolando Alfredo Gimbernat
2017-2019:
José Luis Golubicki
2019-2021:
Rosa Reina
COMITÉS CIENTÍFICOS
Asuntos Laborales
Viviana Romero
Bioética
Lic. Analía Occhiuzzi
Certificación y Revalidación
Alejandro Siaba Serrate
CODEACOM
Richard Montano Buitrón
Ecografía en el Paciente Crítico
Juan Manuel Pina
Emergentología y Respuesta Rápida Intrahospitalaria
Anatilde Díaz
Enfermería en Cuidados Críticos
Lic. Monica Dailoff
Ética en Investigación
Monica Capalbo
FCCS
Pablo Pardo
Género y Diversidad
Analía Occhiuzzi
Gestión, Control de Calidad y Datos
Nancy Boada
Infectología Crítica
Eleonora Cunto
Nefrología Crítica
Nahuel Rubatto Birri
Neonatología Crítica
Liliana Roldán
Neumonología Crítica
Sergio Giannasi
Neurointensivismo
Héctor Álvarez
Obstetricia Crítica
Mariana Kirschbaum
Oncología Crítica
Viviana Reyes
Reanimación Pediátrica
Marcela Cuartas
Patología Crítica Cardiovascular
Karina Lozano
Patología Digestiva en Pacientes Críticos
Elvis Salcedo Noriega
Pediátrico de Neumonología Crítica
Santiago Esquivel
PFCCS
Silvio Torres
Reanimación y Recuperación Cardio Cerebral
Cristina Orlandi
Recuperación Cardiovascular Pediátrica y Neonatal
Rafael Fraire
Sedación, Analgesia y Delirium
Sabrina Di Marco
Seguimiento y Rehabilitación
Lic. Carolina Foster
Shock Pediátrico
Adriana Bordogna
Shock y Sepsis
Luis Gatti
Soporte Nutricional y Metabolismo
Ezequiel Manrique
Soporte Vital Extracorpóreo
Sonia Villarroel Mendoza
Trasplante y Procuración de Órganos y Tejidos
José Juri
Trauma
María Gabriela Vidal
Vía Aérea e Interfaces Respiratorias
Gustavo Benavent
CAPÍTULOS, CONSEJOS Y DEPARTAMENTOS
Capítulo Bioquímico
Fabián Rodríguez
Capítulo Enfermería
Marcelo Fabio Morales
Capítulo Enfermería en Neonatología
Gustavo Sergio Villalba
Capítulo Farmacéutico en Medicina Crítica
Agustina Luconi
Capítulo Kinesiología Intensivista
Gastón Murias
Capítulo Nutrición
Silvia Jereb
Capítulo Pediatría
Gustavo González
Capítulo Veterinario
M.V. María del Carmen La Valle
Consejo de Investigación
Elisa Estenssoro
Consejo Consultivo Asesor
Antonio Gallesio
Departamento Docencia
Adelina Badolati
32º Congreso
Argentino e Internacional de Terapia Intensiva
PRESIDENTA DEL CONGRESO
Rosa Reina
TESORERA DEL CONGRESO
Susana Bauque
COMITÉ EJECUTIVO
Presidente
Daniel Duarte
Vicepresidente
Gustavo Benavent
Secretaria
Jorgelina Guyón
Prosecretaria
Marianela López Martínez
Vocales
Juan José Varela
Eduardo Perrault
COMITÉ CIENTÍFICO
Presidenta
Viviana Romero
Vicepresidenta
Mariel García
Secretaria
Natalia Fernández
Prosecretario
Gabriel Fernández
Coordinadora Nacional
Cristina Orlandi
Vocales
Juan San Emeterio
Silvana Svampa
Osvaldo Rubio
JURADO DE PREMIOS
Presidenta
María Cruz Martín
Cayetano Galletti
Elisa Estenssoro
Eduardo San Román
Fernando Pálizas
REVISIÓN DE TRABAJOS
Cecilia Loudet
Cecilia Pereyra
Fernando Ríos
Marcela Castro
25º Congreso Argentino de Enfermería en Terapia Intensiva
Presidente
José Lozano
Vicepresidenta
Mónica Dalloff
Coordinadora Nacional
Mariana Torres
Vocales
Karina Rohr
Verónica Curilen
24º Congreso Argentino de Kinesiología en Terapia Intensiva
Presidente
Néstor Vicente
Vicepresidenta
Vanesa Alonso
Coordinador Nacional
Mariano Setten
Vocales
Marcos Gil
Ayelén Bagueiro
23º Congreso Argentino de Terapia Intensiva Pediátrica
Presidenta
Mariela Subira
Vicepresidente
Roberto Tomassone
Coordinadora Nacional
Ana Calvo
Vocal
Sara Reginer
18º Jornada Nacional de Bioquímicos en Terapia Intensiva
Presidenta
Karina Andrieu
Vicepresidenta
Ruth Shocron
Coordinadora Nacional
María del Carmen Iñíguez
Vocal
Fabián Rodríguez
15º Jornada del Comité de Neonatología Critica
Presidente
Diego Acosta
Coordinadora Nacional
Liliana Roldán
9º Jornada de Farmacéuticos en Terapia Intensiva
Presidenta
Miriam Bettucci
Vicepresidenta
María Elisa Cánepa
9º Jornada de Lics. en Nutrición en Terapia Intensiva
Presidenta
Paula González
Vicepresidenta
Natalia Aparicio
Vocales
Marilia González
Natalia González
Guillermina Augustu
INVITADOS
EXTRANJEROS
Gustavo Greco (Uruguay)
Daniel Brodie (Estados Unidos)
Michael Pinsky (Estados Unidos)
Jean Louis Teboul (Francia)
Manuel Jibaja (Ecuador)
Javier Urbano Villaescusa (España)
Dolores Escudero (España)
Silvia Pérez Protto (Uruguay)
José Luis Marco Garbayo (España)
Oscar Cabrera Avendaño (México)
Yuliet María Zabaleta Polo (Colombia)
Nexiele González de la Paz (México)
Renata Pietro Viana (Brasil)
Álvaro Fernández (Uruguay)
Eduardo Miñambres (España)
Luciano A. Sposato (Canadá)
Jesús Caballero (España)
Beatriz Domínguez Gil (España)
Monge García (España)
Manuela García (España)
Fernando Pereyra (Colombia)
Humberto Fonseca Cordero (Costa Rica)
Jaime Fernández-Sarmiento (Colombia)
Victoria Gil Navarro (España)
Daren Heyland (Canadá)
Fernando D. Goldenberg (Argentina)
Leo Heunks (Países Bajos)
Lara Pisani (Italia)
Agamenon Quintero Villarreal (España)
Paloma Oliver Sáez (España)
Stefanie Bailey (Estados Unidos)
Stephen Lapinksy (Estados Unidos)
Ramiro Gilardino (Argentina)
Martin Kneyber (Países Bajos)
Alexandre Toledo (Brasil)
Eduardo Lobatón (Estados Unidos)
María Bodi (España)
Claudio Flauzino de Oliveira (Brasil)
José M. Domínguez Roldán (España)
TRABAJOS ORALES
09/11/2022 - 08:00 a
09:00
TRABAJOS ORALES 01
Infectología
Atlántico A
G
Yossa
L
De Vedia, N Lista, A Rodríguez, E Di Virgilio, M Peralta, M Flores Montes, G
Piovano, I Prieto, D Dominguez, V Auteri, E Artigas, L Camargo, G Cabrera, M
Cieslikowski, E Cunto
M
Garcia Sarubbio, MA Mazzoleni, MJ Meschini, C Colavita, V Aramendi, A Barbieri,
C Paez, V Pazos, MC Marchena, MG Sáenz, S Tal Benzecry, CI Loudet
0386 CONSUMO DE ANTIMICROBIANOS EN UNA UNIDAD DE CUIDADOS INTENSIVOS
DE ADULTOS.
M
Garcia Sarubbio, MA Mazzoleni, MJ Meschini, C Colavita, V Aramendi, A Barbieri,
CE Páez, V Pazos, MC Marchena, MG Sáenz, S Tal Benzecry, A Garroni, CI Loudet
09/11/2022 - 08:00 a
09:00
TRABAJOS ORALES 02
Covid 1
Atlántico B
0279 CARACTERISTICAS CLINICAS Y MORTALIDAD DE PACIENTES CON COVID-19
GRAVES Y CRITICOS
E
Cunto, V Chediack, P Saul, A Rodríguez, R Gregori-sabelli, C Dominguez, ME
Artigas, Y Lamberto, M Flores Montes, I Prieto, JM Fernández, MI Calderón, N
Chacón, E Lista, L De Vedia
0307 CARACTERÍSTICAS Y EVOLUCIÓN DE LA INFECCIÓN GRAVE POR SARS-COV-2
EN PERSONAS VIVIENDO CON VIH
L
De Vedia, V Chediack, S Cáceres, D Dominguez, L Gonzalez, N De Grazia, O
Ortuño, V Auteri, P Velazquez, G Piovano, E Cortes, E Di Virgilio, E Artigas, E
Cunto
0334 TERAPIA DE REEMPLAZO RENAL CONTINUA DE PACIENTES CRITICOS EN
PANDEMIA
R
Gregori Sabelli, C Dominguez, Y Lamberto, P Saul, V Fernandez Abello, J
Fernandez, A Bocassi, E Cortez, L Doldan, O Ortuño Cerezo, S Caceres, C Vargas,
N Chacon, V Chediack, E Cunto
0346 EVOLUCIÓN DE PACIENTES TRAQUEOSTOMIZADOS COVID Y NO COVID
F
Amieva, G Ramos, V Picolla, R Fiorentino, N Arias, A Carusso, A Enrique, R
Mattei, E Soler, M Ducassa, M Salazar, B Paula, B Melanie, C Carlos
A
Feldman, J Aguirre, C Lopez, D Varela, M Aliaga, S Tomez, B Daglio, M
Lompinzano, S Fredes, N Tiribelli, D Quaranta
A
Feldman, J Aguirre, C Lopez, D Varela, M Aliaga, S Tomez, B Daglio, M
Lompinzano, S Fredes, N Tiribelli, C Benay, D Quaranta
09/11/2022 - 09:00 a
10:00
TRABAJOS ORALES 03
Covid 2
Atlántico B
CE
Maenza, NS Rocchetti, M Ramírez Colombres, M Latimori, FR Dipaolo, F Garavelli,
SP Gattino, MD Ré, CJ Settecase, DH Bagilet
G
Genovese, MS Tomez, M Deguardia, RG Ochoa, VN Terrazas Cruz, AK Marquez, IF
González Marquez, H Mamani Sánchez, MDLM Picos, A Antik, R Rodrigues La Moglie,
B Spath, FM Dana, M Izus
R
Mattei, G Covello, S Gigena, EM Noli, M Bezzi, S Borello, G Jove, D Masuello,
ML Laurens, M Mastandrea, G Rodriguez D´aversa, N Suarez, F Rodriguez, L
Silvani
C
Gonzalez, G Musso, JR Louzan, G Appendino, C Gomez, D Latasa, A Lopipi, J
Rango, S Calabrono, G Sterzer, L Finos, M Cavagnari, G Suarez, G Alessio, L
Berloni, E Pizzo, A Abarca, L Clemente, M Manago, C Lovesio, E Estenssoro
0261 IMPLEMENTACION DE CANULA NASAL DE ALTO FLUJO EN PANDEMIA COVID-19
A
Gira, E Bellone, V Pousa, P Pratesi
0289 PREDICCIÓN DE MORTALIDAD EN NEUMONÍA GRAVE POR COVID 19 MEDIANTE
ALGORITMO DE MACHINE LEARNING
A
Antik, G Genovese, MS Tomez, M Deguardia, R Ochoa, V Terrazas Cruz, AK Marquez,
I González Marquez, H Mamani Sánchez, MDLM Picos, F Dana, M Izus
09/11/2022 - 08:00 a
09:00
TRABAJOS ORALES 04
Neumonología-Kinesiología Crítica 1
Courrier Atlántico
0041 TRAQUEOSTOMÍA EN PACIENTES CON COVID-19 ¿LA DISFAGIA CONDICIONA
EL TIEMPO DE DECANULACIÓN?
ME
Catini, A Falduti, G Chiappero
HA
Armandola, S Izza, EN Diaz Rousseaux
E
Picos, J Joaquin, I Castro, R Aranda, B Fradin, V Fiorentini, E Dutto, P
Desousa, P Staffolani, G Frankenberger, S Alvarez
S
Gigena, MG Covello, EM Noli, M Bezzi, S Borello, R Mattei, G Jove, D Masuello,
ML Laurens, M Mastandrea, G Rodriguez D´aversa, N Suarez, F Rodriguez, F
Gonzalez Piña
09/11/2022 - 08:00 a
09:00
TRABAJOS ORALES 05
Pediatría 1
Courrier Boulevard
KM
Manzur, MS Menghi
J
Caridi, L Viterbo, E Monteverde, P Neira
0229 INCIDENCIA DE DELIRIUM EN UNA UNIDAD DE CUIDADOS INTENSIVOS
C
Garcia Laplaza, C Berrondo, E Monteverde
0278 LESIÓN RENAL AGUDA EN NIÑOS CURSANDO POSTOPERATORIO DE CIRUGÍA
CARDIOVASCULAR
M
Sanz, P Reyes
A
Bordogna, G Aparicio, P Castellani, C Lutkevicius, M Mendoza, M Rabino
0384 TRASPLANTE HEPÁTICO CON DONANTE VIVO: UNA OPORTUNIDAD CRECIENTE
J
Castro Méndez, P Reyes, I Malla, M Fauda, T Iolster, AJ Siaba Serrate, S Torres
09/11/2022 - 08:00 a
09:00
TRABAJOS ORALES 06
Trasplante-Neurointensivismo
Dauphine
0054 EXPERIENCIA DEL USO DE DUPPLEX TRANSCRANEAL EN UNA UNIDAD DE
CUIDADOS CRITICOS INFECTOLOGICA
Y
Lamberto, P Saul, C Dominguez, R Gregori-sabelli, N Chacon, J Fernandez, S
Caceres, L Gonzalez, P Velazquez Lopez, MDLM Nano, G Sandez, V Chediack, E
Cunto
DA
Rodriguez, P Centeno, M Petre, F Puzzo, M Anchorena, J Aldana Diaz, D Ortega
Rodriguez, L Sanabria, X Benavente
DA
Rodriguez, P Centeno, F Puzzo, L Sanabria, B Murguía, M Petre, M Domanico, E
Duarte, M Anchorena
FE
Kulik, VR Giudicce, TC Navarro Toffaletti, VV Espindola, FN Falcon, ML
Braccini, AE Piacenza
0335 DONACIÓN EN ASISTOLIA CONTROLADA EN UN HOSPITAL PÚBLICO DE
ARGENTINA. SERIE DE CASOS
MR
Domanico, DA Rodriguez, E Duarte, P Centeno, M Anchorena, M Petre, X Benavente,
J ángulo, R Canelon, D Ortega Rodriguez, E Montiel, G Duca, J Gelline Garcia, M
Ramirez, NB Leales
09/11/2022 - 08:00 a
09:00
TRABAJOS ORALES 07
Nutrición-Gastrointensivismo
Nonna 1
D
Carelli, M Antonini, R Lema
0284 LINFOPENIA EN EL PACIENTE
CRÍTICO CON Y SIN OBESIDAD
R
Gregori Sabelli, V Fernandez Abello, P Saul, C Dominguez, MB Della Paolera, Y
Lamberto, M Abot, S Caceres, M Galindo, N Chacon, M Noceto, MDLM Nano, V
Chediack, E Cunto
0301 CALORIMETRÍA INDIRECTA SEGÚN EL TIEMPO DE ESTADÍA EN TERAPIA
INTENSIVA
MJ
Reberendo, F Gutierrez, AH Reque Panozo, ND Llobera, CA Navarro Pabon, SP
Chapela
0302 CALORIMETRÍA INDIRECTA EN PACIENTES OBESOS EN VENTILACIÓN
MECÁNICA
ND
Llobera, F Gutierrez, AH Reque Panozo, MJ Reberendo, CA Navarro Pabon, SP
Chapela
F
Gutierrez, EJ Descotte, MJ Reberendo, ND Llobera, M Pozo, SP Chapela
09/11/2022 - 08:00 a
09:00
TRABAJOS ORALES 08
Gestión
Nonna 2
0040 COMPOSICIÓN DEL GASTO EN LA UTI DEL HOSPITAL ITALIANO DE ROSARIO,
EN UN PERÍODO DE 6 MESES
E
Vera, R Pellini
0055 SAPS III: DESEMPEÑO EN UN SERVICIO DE CUIDADOS INTENSIVOS MIXTO
EN ARGENTINA
R
Fernandez
G
Vecchio, J Sanchez
0199 CAMBIOS PRE Y POST PANDEMIA EN LA UTI DEL HOSPITAL COMUNITARIO DE
PINAMAR
C
Mendoza Hadad, VH Rogers, M Aquino, MR Ayala, L Bobone, A Colombani, D
Curuchet, JA Chuquipoma Diaz, E Deza Chingel, GP Formica, A Gabrieloni, ME
Garcia, ME Gonzalez, L Guzmán Cerezo, V Mandich, M Melia, G Perez, M Porco, J
Pui, YM Pui, JA Rodriguez, WH Sommer, K Valdiviezo Acuña
0207 UTILIZACION DE RECURSOS PRE Y POST PANDEMIA EN LA UTI DEL
HOSPITAL COMUNITARIO DE PINAMAR
C
Mendoza Hadad, VH Rogers, M Aquino, MR Ayala, L Bobone, A Colombani, D
Curuchet, JA Chuquipoma Diaz, E Deza Chingel, GP Formica, A Gabrieloni, ME
Garcia, ME Gonzalez, L Guzmán Cerezo, V Mandich, M Melia, G Pérez, M Porco, YM
Pui, J Pui, JA Rodriguez, WH Sommer, K Valdiviezo Acuña
10/11/2022 - 08:00 a
09:00
TRABAJOS ORALES 09
Nefrología-Shock-Cardio
Nonna 1
A
Guzzetti, P Zielinksi, M Teheran Wilches, L Pulido Blanco, C Basañes, L Rocha
Rivarola, F Allalla, A Savia
FC
Rosciani, VA Ruiz, I Carboni Bisso, S Di Stefano, SE Giannasi, FG Wright, MA
Sian, FL Negri Rico, C Juana, G Galli, MJ Las Heras, I Fernández Ceballos
DP
Acosta, D Vazquez, N Fermin Paredes, W Rosales, C Bernal, S Eiguren, L Bucetta
C
Gomez, A Peralta, A Urquhart, F Fretes, T Scholtz, N Galeano, P Rolon, H
Bianco, F Ferreira, B Figueredo
10/11/2022 - 08:00 a
09:00
TRABAJOS ORALES 10
Covid 3
Atlántico A
E
Martinez, C Aguilera, D Marquez, V Sturzenegger, C Cimino, E Hidalgo, H
Escobar, S Piombi Adanza, G Zielger, L Tschopp, C Cominotti, J Plumet, C
Pereyra
MV
Saucedo, NC Rumbo, I Castro, SV Santarelli, CE Lopez, E Barimboin, E Zirulnik,
SS Alvarez
0098 SOBREVIDA Y ESTADO FUNCIONAL AL AÑO EN PACIENTES VENTILADOS POR
COVID 19
G
Echavarria, M Gutierrez, E Sobrino, G Badariotti, P Sabaté, A Manchado, P
Lavorato, P Lopez, M Durlach, I Raguzzi, A Luconi, G Galego, B De Diego
S
Sciuto, MM Santini, PR Peral, FE Villagra, EM Arocena, JN Martínez Nehin, I
Zabert, GE Zabert
D
Vasquez, R Giannoni, A Salvatierra, K Cisneros, D Lafosse, F Escobar, M
Montenegro, P Juárez, L Visani, V Mandich, E Barrozo, M Kirschbaum, G
Plotnikow, MF Valenti, MC Canseco, I Romero, P Macharé, A Marquez, E Rodriguez,
C Palacio, L Rapela, J Amillategui Scenna, R Nuñez, S Torres, MA Gonzalez, L
Franconieri, A Das Neves, D Nasner, P Okurzaty, AD Intile
D
Vasquez, R Giannoni, A Salvatierra, K Cisneros, D Lafosse, F Escobar, M
Montenegro, P Juárez, L Visani, V Mandich, E Barrozo, M Kirschbaum, A Das
Neves, MF Valenti, MC Canseco, I Romero, P Macharé, A Marquez, E Rodriguez, C
Palacio, L Rapela, J Amillategui Scenna, R Nuñez, MA Gonzalez, S Torres, L
Franconieri, G Plotnikow, D Nasner, P Okurzaty, AD Intile
10/11/2022 - 08:00 a
09:00
TRABAJOS ORALES 11
Neumonología-Kinesiología Crítica 2
Courrier Atlántico
V
Ruiz, F Rosciani, I Carboni Bisso, I Fernandez Ceballos, M Las Heras, C
Lockhart, J Cantos
0059 INTUBACIÓN POR LARINGOSCOPIA CONVENCIONAL VS VIDEOLARINGOSCOPIA
EN OPERADORES INEXPERTOS
MA
Vargas, VV Espíndola, LP Marzoratti, TC Navarro Toffaletti, ÁE Piacenza
F
Guzmán Tapia, JC Uribe Caballero, S Castro, ML Salazar Hernandez, A Fray, M
Flores, M Morante
0156 INCIDENCIA DE COMPLICACIONES TARDÍAS EN TRAQUEOSTOMIAS
PERCUTÁNEAS
VI
Reichert, N Carrizo, A Marozzi, M Filippi, L Morano, R Avila
10/11/2022 - 08:00 a
09:00
TRABAJOS ORALES 12
Covid 4
Courrier Boulevard
J
González Anaya, I Carboni Bisso, V Ruiz, M Baglioni, E Villanueva, I Huespe, S
Di Stefano, M Las Heras, M Falconi, J Sinner
P
Delgado, V Mercado, G Granado
E
Arana Osorio
0082 PRUEBA DE EJERCICIO CARDIO-PULMONAR Y SPECT PULMONAR V/Q POSITIVO
EN PACIENTES POST-COVID
LG
Duran, L Melatini, T Papucci, JM Via Alvarado, M Colucci
0131 MONITOREO DEL AGUA EXTRAVASCULAR PULMONAR EN COVID -19
D
Duarte, G Benavent, A Monson, Y Escobar, D Espinel, E Sanchez, J Roldan, R
Sanabria
10/11/2022 - 08:00 a
09:00
TRABAJOS ORALES 13
Pediatría 2
Dauphine
V
Bas, M Jofre
JI
Simonassi, MT Canzobre, M Ricciardelli
C
Berrondo, C Laplaza, J Caridi, R Martínez, L Viterbo, L Faure, J Salvatierra, R
Pasmiño, E Barlassina, D Mujica
0183 IMPLEMENTACIÓN DE CHECK LIST DIARIO COMO MEJORA DE LA SEGURIDAD
DEL PACIENTE EN UNA UCIP
C
Berrondo, E Monteverde, M Garea, P Neira
11/11/2022 - 08:00 a
09:00
TRABAJOS ORALES 14
Covid 5
Atlántico A
G
Musso, M Mangó, MC Gomez, G Appendino, L Friscione, C Gonzalez, C Capitaine
Funes, F Piatti, C Lovesio
0025 MONITOREO REMOTO DE LA GLUCEMIA DURANTE LA PANDEMIA SARS-COV-2:
SERIE DE CASOS
L
Bujan Molins, I Carboni Bisso, F Garelli, H De Battista, R Sánchez-peña, E San
Román, L Grosembacher, M Las Heras
A
Potenzoni, Y Benavente
0090 ASPERGILOSIS PULMONAR ASOCIADA A COVID-19: UNA MIRADA
RETROSPECTIVA
NI
Zelaya De Leon, CJ Beroiza, M Cruz, LG Duran, NA Grassi, AV Millán, MG
Montenegro Fernandez, M Petasny, P Zorzano Osinalde
ML
Cazzola, MS Ocampo, MV Benito, MB Mijalski, A Cremona
DISCUSIÓN DE POSTERS
ELECTRÓNICOS
09/11/2022 - 14:00 a
15:30
Discusión de Posters Electrónicos 01
Cardiología 1
Columnas del
Boulevard
0206 SÍNDROME CORONARIO AGUDO SECUNDARIO A ROBO CORONARIO: A PROPÓSITO
DE UN CASO
N
Grassi, CJ Beroiza, M Cruz, LG Durán, VA Millán, MG Montenegro Fernandez, M
Petasny, NI Zelaya De León, P Zorzano Osinalde
0239 INSUFICIENCIA TRICUSPÍDEA TRAUMÁTICA
A
Ramirez Juncos, PB Pahnke
0263 PARO CARDIORRESPIRATORIO RECUPERADO SECUNDARIO A SÍNDROME DE
TAKOTSUBO. PRESENTACIÓN DE CASO
GM
Garelli, SB Soli, JJ Storani, DS Diaz
0294 COMUNICACIÓN INTERVENTRICULAR MULTIPLE, COMPLICACION GRAVE Y POCO
FRECUENTE POST INFARTO
S
Gasparotti, LM Rodriguez, FP Bertoletti
0317 SINDROME
POSTPERICARDIOTOMIA TRAS CIRUGIA CARDIACA
J
Quiroz Cedeño, G Monti, F Perez, G Gaudenzi, P Verta, M Rolando, O Ferrufino, K
Banzer, M Mansur, K Gamarra, A Canchila, D Parraga, A Fernandez, A Gonzalez, D
Mingoni
0332 ATURDIMIENTO MIOCARDIACO NEUROGENICO EN UN PACIENTE CON SLPR.
PRESENTACION DE UN CASO
M
Martinez, LC Avila, EC Rodriguez
0347 DISECCIÓN DE ARTERIA PULMONAR ASOCIADO A FIBROSIS PULMONAR
IDIOPATICA
M
Singh, F Am, J Moreno, R Santillan, S Gerez, DA Mariana, N Orosco, F Enriquez,
L Panozo, A Jove, J Salvadores
P
Melchiori, D Abila, E Guerrero, P Bucciarelli, C Santilli, H Rothe, P Brenzoni
0402 TROMBOEMBOLISMO
PULMONAR SECUNDARIO A DISECCION DE LA ARTERIA PULMONAR: A PROPOSITO DE UN CASO
MA
Misa, A Brañez Toro Yasmani, DC Rodriguez, CL Landoni, A Brizuela, JP Soliz, J
Vazquez, S Roldan Montaño, A Luzzi, J Lescano
09/11/2022 - 14:00 a
15:30
Discusión de Posters Electrónicos 02
Covid 1
Columnas del
Boulevard
0009 VIABILIDAD DEL POSICIONAMIENTO EN DECÚBITO PRONO CON UN ÚNICO
OPERADOR: DESCRIPCIÓN TÉCNICA
A
Masso, N Gemelli, G Sotera, C Barrios, D Pina, I Carboni Bisso, M Las Heras
U
Zaya, A Aliscioni, Y Saldivar, R Alvarez, F Irades, N Kessler, P Tejerina, C
Firme, P Calcagno, E Minoldo, C Galletti
0153 MIASTENIA GRAVIS DE NUEVA APARICION POST VACUNACION CONTRAL EL SARS-COV-2.
REPORTE DE CASO
M
Martinez, LC Avila, EC Rodriguez
0268 HALLAZGOS TOMOGRAFICOS ATÍPICOS EN PACIENTES COVID 19 Y SU ASOCIACIÓN CON TOCILIZUMAB
DN
Gauna, A Dubin, N Benassich, C Zapata, A Leporace, C Alquichire, R Bastidas, M
Palmas, P De Leon, I Swoboda, A Guevara, S Gallego, L Sambrana, G Lopez, D
Colosima, V Kanoore Edul, N Rubatto, M Mugno
0275 USO DE HELMET COMO HERRAMIENTA TERAPÉUTICA EN PACIENTES CON
NEUMONÍA POR COVID-19
JP
Arduino, S Pulcinelli, D Souto, D Sanchez, D Cattalini
0324 COAGULOPATÍA INDUCIDA POR COVID. REPORTE DE CASO
JJ
Cáceres, FD Vasile, MA Vega, DA Sittoni, JR Bagnasco, NV Luna
0326 MIOCARDITIS POR SAR COV-2 EN PACIENTE INMUNOCOMPROMETIDA. REPORTE
DE CASO
G
Fernandez, V Cuéllar, C Miglioranza, S Viera, P Dominguez, N Rizzo, P Zenón, P
Artaza, A Bucci, H García, R López, MM Tártara, S Urbano, L Migliacci, P Verón
0364 TAKOTSUBO ASOCIADO A SINDROME DE DISTRES RESPIRATORIO AGUDO POR
COVID-19
M
Singh, F Am, J Moreno, R Sanitllan, S Gerez, L Panozo, A Jove, N Orosco, F
Enriquez, M Dell Aqcua, S Ramos, J Salvadores
0375 TROMBOCITOPENIA TROMBÓTICA INMUNE INDUCIDA POR LA VACUNA (VITT)
ASTRAZENECA - REPORTE DE CASO
E
Viscarra, G Tajes, L Del Tiempo, M Magrini, E Choque, N Segura, A Santa Maria,
M Berté, D Noval, S Ilutovich
LC
Perez Illidge, L Aguirre, G Tuhay, N Peña, ML Ojeda, S Finoli, M Acebo, E
Giordanino, R Pantoja, F Klein
09/11/2022 - 14:00 a
15:30
Discusión de Posters Electrónicos 03
Gastroenterología y Nutrición 1
Columnas del
Boulevard
0205 PROBIÓTICOS: ¿SON REALMENTE INOFENSIVOS?
GL
Capdevila Vicente, PB Pahnke, MC Vignetta, S Paván, A Lopez, I Herrero, MV
Vignolo, I Ocampo, S Cabiedes
0223 NECROSIS ESOFÁGICA AGUDA EN PACIENTE CRÍTICAMENTE ENFERMO:
REPORTE DE CASO
CF
Chavez, F Ferreira, L Soliz, J Cardozo, R Dominguez, MB Vazquez, JC Galarza, C
Pozo, N Grubissich, D Pina
0256 REPORTE DE CASO: SÍNDROME DE ARTERIA MESENTÉRICA SUPERIOR O
SINDROME DE WILKIE
V
Iglesia, L Peralta, N Tedone, F Villarejo, D Piezny, R Rotte, S Helguera, D
Pezzola, C Arias, L Medina, L Magnifico
ML
Morales, L Ruarte, M Garcia, P Taborda, J Ortega, A Quinteros, S Rojas, C
Ferreyra, D Carranza, N Bonetto, S Carrizo, J Celia, M Ruiz, M Buemo
0300 EL MÚSCULO MEDIDO EN LA TOMOGRAFÍA DE TÓRAX NO PREDICE MORTALIDAD
EN TERAPIA INTENSIVA
SP
Chapela, M Aquino, MJ Reberendo, L Carmona Diaz, ND Llobera, C Peñaranda, A
Garcia
0400 PANCREATITIS AGUDA SECUNDARIA A HIPERTRIGLICERIDEMIA SEVERA.
PRESENTACIÓN DE CASO
G
Garelli, GM Garelli, JJ Storani, SB Soli, DS Diaz
M Ramon, M Singh, N
Aguer, F Am, J Moreno, S Ramos
09/11/2022 - 14:00 a
15:30
Discusión de Posters Electrónicos 04
Infectología 1
Columnas del
Boulevard
0288 ABSCESO CEREBRAL CON RUPTURA HACIA SISTEMA VENTRICULAR POR
STREPTOCOCCUS INTERMEDIUS
VD
Toledo, M Montenegro, A Violo, AC Di Nuzzo, A Ojeda, R Lobo, J Sereno, M
Centurion, F Alsina, E Mikulic
0293 PATOLOGÍA POR CONSUMO DE CONSERVAS: BOTULISMO EN EL NOA, REPORTE
DE CASOS
AM
Sanchez, AN Vides, N Saragusti, N Llanes, R Retambay, MC Sotelo, M Corona, J
Maidana, R Reinoso
I
Colman, J Figueredo, F Fretes, L Fontclara, J Cabral, R Paez, R Caballero, J
Pereira, H Bianco, B Figueredo
0299 REPORTE DE UN CASO: SÍNDROME DE ABSCESO HEPÁTICO INVASOR POR
KLEBSIELLA PNEUMONIAE
K
Banzer, G Monti, G Gaudenzi, C Llerena, J Quiroz, O Ferrufino, M Rolando, M
Mansur, F Perez, D Parraga, K Gamarra, A Canchila, A Fernandez, A Gonzalez, D
Mingoni
M
Galindo, P Saul, MDLM Nano, G Sandez, F Gil Zbiden, JM Fernandez, C Vargas, N
Campagnucci, A Pacovich, ME Ibarra, E Cortez, P Velazquez, V Chediack, ER Cunto
J
Salvadores, F Am, S Ramos, N Marquez, V Barrozo, M Singh, B Olocco
C
Sotelo, A Vides, M Corona, J Maidana
0376 TROMBOSIS CEREBRAL RETARDADA COMO COMPICACION DE MENINGITIS POR
S. PNEUMONIAE
DF
Párraga, G Monti, C Llerena, G Gaudenzi, M Rolando, J Quiroz, K Banzer, O
Ferrufino, M Mansur, F Perez, K Gamarra, A Canchila, A Fernandez, A Gonzales, D
Mingoni
A
Jora, C Colque Espada, ME Boazzo, Y Juarachy, R Quisbert, Y Ramos Alcaraz, JC
Garcia, C Farias
AN
Pérez Murúa, M Jaume, MF Piñeiro, MP Cordero, D Lafosse, A Tristaíno, L Pero, B
Castro, D Dobricich, K Cisneros, E Porjolovsky, L Franconieri
09/11/2022 - 15:30 a
17:00
Discusión de Posters Electrónicos 05
Pediatría 1
Columnas del
Boulevard
0165 REPORTE DE UN CASO DE MAL DE POTT EN UN LACTANTE
L
Menta, E Paz, A Coca Salazar, A Dalzotto, C Olivera, C Karina
S
Magee Bahl, P Neira, E Monteverde, D Turina
M
Pazmino, R Alvarez, J Velez, C Fridman
G
Gonzalez, F Pavone, A Lepore, PZ Vladimir, M Ludueña, A Guillermo, A Maria
Fernanda, M Pablo, L Marta
0305 VEXUS: NUEVO SISTEMA DE VALORACION VENOSA CON POCUS
AS
Avila Vera, J Bleis
PL
Bureu, SM Romero Baldoni, MI Subira
0325 REPORTE DE CASO: FALLO RESPIRATORIO POR QUISTE DE VALÉCULA Y
MANEJO EN LA URGENCIA
M
Enriquez Gentile, L Martinez, C Mena, A Bottaro, D Natta, P Medici, M Nogueira,
J Gonzalez, D Jauregui
G
Fagalde, C Chavez, L Ramasco, S Gabriela, R Alejandra, J Paula, C Paula, P
Hugo, T Rubén, PC Pablo, R Magdalena, C Ezequiel
M
Pazmino, M Giampieri, M Gonzalez, C Lutkevicius, P Castellani, M Rabino
09/11/2022 - 15:30 a
17:00
Discusión de Posters Electrónicos 06
Nefrología y Medio Interno
Columnas del
Boulevard
0038 TOXICIDAD Y FALLECIMIENTO DE 2 PACIENTES POR CONSUMO DE THEVETIA
AHOUAI EN NORTE DE SANTANDER
LA
Dulcey Sarmiento, JS Theran Leon, R Caltagirone, IC Assaf Seguias, V Cabrera
Peña, AL Ruge Serrano, JA Pineda Parada, JJ Barbosa Del Castillo, MJ Aguas
Cantillo, RG Parales Strauch, A Quintero Romero
F
Cometto, M Jaime, HA Trillard, M Binci Vayer, S Dipente, E Guzman, S Mattausch
0125 SÍNDROME RIÑÓN-PULMÓN EN PACIENTE CRÍTICO. REPORTE DE UN CASO
CLÍNICO
F
Cometto, M Jaime, HA Trillard, M Binci Vayer, S Dipente, E Guzman, S Mattausch
M
Gonzalez, JE Alfonso, LJ Ojeda Flores, KV Velazco Velazquez, LF Solis, LB
Costa, C Pisarello, MA Perez Scetti, C Mizdraji, LG Huespe, S Lazzeri, JC
Garcia Roth, H Alvarez
0215 TOXICIDAD POR METFORMINA: PRESENTACIÓN DE UN CASO CLÍNICO
MA
Balauz, M Ducasa Torres, P Balmaceda, M Salazar, F Amieva, GE Ramos, V Picolla,
CB Cozzani
0234 ACIDOSIS LACTICA SECUNDARIO A INTOXICACION POR METFORMINA
P
Zuleta Chambi, A Bonilla, E Polo, J Rivadeneira
0270 GLOMERULONEFRITIS: PRESENTACION ATIPICA
A
Gonzalez, G Tocalli, A Baez, M Lotorto, C Canteli, S Lujan
0318 CUANDO LA INTERPRETACION DEL ESTADO ACIDO-BASE ES LA CLAVE DEL
DIAGNOSTICO. REPORTE DE UN CASO
CM
Dimarco, G Velazco, V Saucedo, C Lopez, S Saltarelli, G Fernandez, S Alvarez, S
Saracco
0328 UTILIDAD DE LA VENA YUGULAR INTERNA PARA HEMODIÁLISIS DE URGENCIA
EN PACIENTES ORTOPNEICOS
R
Karatanasopuloz, MM Barraza, SA Gimenez Pedemonte, JC Florez, A Serruya, G
Levy, L Gossen, MF Mendieta, C Joachin
0330 INGESTA SUBREPTICIA DE FUROSEMIDA: MANIFESTACIONES
HIDROELECTROLITICAS Y DERMATOLOGICAS
DN
Gauna, M Daniel, F Benavente, MP Etchemendi, A Dubin
0410 ACIDOSIS PIROGLUTÁMICA CON GAP ELEVADO ASOCIADO A CONSUMO DE
PARACETAMOL
MB
Pollian, M Cuestas Rios, F Loiacono, J Sagardia, N Balderrama
09/11/2022 - 15:30 a
17:00
Discusión de Posters Electrónicos 07
Neumonología-Kinesiología 1
Columnas del
Boulevard
0060 NEUMOMEDIASTINO, NEUMOTÓRAX BILATERAL Y NEUMORRAQUIS EN CRISIS
ASMÁTICA SEVERA
M
Latimori, F Garavelli, F Dipaolo, M Ramirez Colombres, CE Maenza, MD Ré, SP
Gattino, NS Rocchetti, CJ Settecase, DH Bagilet
Z
Carlos Matías Ezequiel, ML Braccini, DE Miño, TC Navarro Toffaletti, P Piacenza
JC
Uribe Caballero, F Guzman, S Castro, ML Salazar Hernandez, A Fray, M Flores, M
Morante
MA
Sabbatini
0107 TERAPIA DE ALTO FLUJO EN TRAQUEOSTOMÍA COMO ESTRATEGIA EN DESTETE
PROLONGADO: REPORTE DE CASO
AE
Gomez, JI Fernandez, O Reniero, ME Dure
0115 COLAPSO SUBGLÓTICO TRAQUEAL SUPRAOSTOMÍA COMO FALLA EN EL PROCESO
DE DECANULACIÓN
G
Chiappero, A Falduti, ME Catini
0128 REHABILITACIÓN BASADA EN LA FAMILIA EN PACIENTES NEURO-CRÍTICOS.
IMPACTO EN LA FUNCIONALIDAD
R
Gomez, E Pereyra Zamora, V Monrroy, D Valdivia, L Castro, M Prodi
AL
Ramirez Ayala, M Gilli
09/11/2022 - 15:30 a
17:00
Discusión de Posters Electrónicos 08
Neurointensivismo 1
Columnas del
Boulevard
0002 TROMBOSIS VENOSA CEREBRAL: VARON JOVEN
E
Simes
C
Videla, P Plou, L Valencia Chicue, C Yampolsky, P Ajler, N Ciarrocchi
W
Dávalos, S Torres, A Rivera, N Vergottini, A Massó, R Quiroga
0045 NORSE (NEW ONSET REFRACTORY STATUS EPILEPTICUS) CAUSADA POR MICOSIS PROFUNDA (FEOHIFOMICOSIS)
A
Gira, A Figueroa, G Mast, R Andrade, P Pratesi
0062 CAVERNOMA EN TRONCO ENCEFÁLICO CON HEMORRAGIA RECURRENTE: REPORTE
DE CASO
AV
Millán, CJ Beroiza, M Cruz, LG Duran, NA Grassi, MG Montenegro Fernández, M
Petasny, NI Zelaya De Leon, P Zorzano Osinalde
0063 ENCEFALITIS AUTOINMUNE COMO CAUSA DE ESTATUS EPILEPTICO NO
CONVULSIVO: REPORTE DE CASO
J
Voss, JI Moreno, R Segovia, N Muicela, A Ayarde, N Tanel, D Ullunque, L Rocha,
F Freile, A Aliaga, G Jacob, L Alejandra, M Nahra
L
Solis, JE Alfonso, L Ojeda Flores, K Velazquez, LB Costa, C Pisarello, Y
Lesieux, MV Ivan, C Mizdraji, L Huespe, S Lazzeri, H Alvarez, JC Garcia Roth
FR
Dipaolo, L Marcos, G Florencia, RC Maria, M Carolina, R Melisa, G Silvana, R
Nicolas, S Claudio, B Daniel
0093 ENCEFALITIS DE BICKERSTAFF: A PROPÓSITO DE UN CASO
F
Delgado, C Ottaviani
0110 ENFERMEDAD NEUROMUSCULAR AGUDA: CRISIS MIASTÉNICA. REPORTE DE DOS
CASOS
MS
Fachinat, V Leiva, M Franco, D Villani, L Leit, E Matijacevich, M Marino, C
Lattanzio, R Rodriguez, M Fuente, R Visintin, J Lassaga, B Jimena
10/11/2022 - 14:00 a
15:30
Discusión de Posters Electrónicos 09
Cardiología 2
Columnas del
Boulevard
0035 COMA MIXEDEMATOSO CON INSUFICIENCIA CARDÍACA AGUDA EN SU
PRESENTACIÓN: REPORTE DE CASO
J
Montesinos, J Gutierrez, F Mejía
0112 SÍNDROME DE AORTA MEDIA, EXCEPCIONAL CAUSA DE EMERGENCIA
HIPERTENSIVA EN ADULTOS
S Gasparotti, LM
Rodriguez, FP Bertoletti, S Calegaris
0121 LA INSUFICIENCIA CARDÍACA AGUDA COMO MANIFESTACIÓN DE LA
TIROTOXICOSIS: A PROPÓSITO DE UN CASO
MG
Montenegro Fernandez, CJ Beroiza, MM Cruz, LG Duran, NA Grassi, AV Millàn, M
Petasny, NI Zelaya De Leon, P Zorzano
0152 PERICARDITIS CONSTRICTIVA: A PROPÓSITO DE UN CASO
I
Bollati, N Buzzi, A Garcia, M Brizuela, E Asinari
0155 HEMATOMA INTRAMIOCARDIO DISCECANTE POST INFARTO AGUDO MIOCARDIO
YS
Talmas Hurtado, N Tello, L Del Rio, G Izzo, E Velasquez, J Angulo, E Rodriguez
A
Couso, S Benavides, A Canedo Bermudez, M Ortiz, S Pello, F Amieva, M Ducasa, V
Picolla, G Ramos, CB Cozzani
LC
Martinez Rigo, M Enriquez Gentile, C Mena, A Bottaro, P Medici, M Nogueira, JE
Gonzalez Rapana, D Jauregui, D Natta, R Diaz, J Aranda, G Navarro, A Carrano
0380 REPORTE DE CASO: INSUFICIENCIA HEPÁTICA SECUNDARIA A AMIODARONA
CM
Mena, PL Medici, A Bottaro, M Enriquez Gentile, LC Martinez Rigo, MA Nogueira,
JE Gonzalez Rapana, C Assali
0398 MEDIASTINITIS POST CINECORONARIOGRAFIA
EM
Choque Ortiz, G Tajes, E Viscarra, A Santa Maria, M Berté, N Segura, D Noval, S
Ilutovich
M
Isa
10/11/2022 - 14:00 a
15:30
Discusión de Posters Electrónicos 10
Covid 2
Columnas del
Boulevard
0003 ENCEFALITIS DESMIELINIZANTE AGUDA (EDA)
E
Simes, N Llanos, C Fernandez
SI
Ramos Elizagaray, F Asenatto, LH Llano Lopez
E
Asinari, A Garcia, N Buzzi, I Bolatti, L Pesce Brochero, A Furlotti, M Olave
Avila
K
Velazquez, L Huespe, L Ojeda Flores, L Solis, M Gonzalez, LB Costa, C
Pisarella, M Perez Scetti, C Mizdraji, S Lazzerri, JE Alfonso, H Alvarez, M
Bovetti, L Rodriguez, CJ Segovia
0108 TEAM COVID EN PANDEMIA POR SARS-COV 2
D
Duarte, G Benavent, A Monson, D Espinel, Y Escobar, E Sanchez, M Maidana, R
Sanabria, J Roldan, N Raimondi
NE
Sanchez, MA Quijano
0141 OSIFICACIÓN HETEROTÓPICA EN COVID-19, ¿LA ASOCIACIÓN AÚN NO
DOCUMENTADA? REPORTE DE DOS CASOS
L
Aren, GF Mayer, J Hernandez
AE
Garrido, AE Piacenza, TC Navarro Toffaletti, CB Lopez, FN Falcon
0178 DECÚBITO PRONO PROLONGADO EN PACIENTES COVID-19 EN VENTILACIÓN MECÁNICA. ESTUDIO RETROSPECTIVO
MD
Celano, JC Melero, EA Di Salvo, VS Acevedo, MP Loustau, I González, CB
Dominguez, FJ Bianchini, MR Del Bono, I Brozzi, GD Garay, FJ Gutierrez, G
Murias, GA Plotnikow
MM
Balceda, M Lamas, DS Crespo, GR Cruz, C Caceres, N Palacio, G Rodriguez, P
Baez, O Lopez, V Gallardo, P Balceda, V Limon, C Tintilay, D Sajama
0321 EL USO DE SEDOANALGESIA EN PANDEMIA POR SARS-COV-2 Y SU IMPACTO
EN UN HOSPITAL MONOVALENTE
D
Raggio, MJ Ochoa, E Cunto, M Quinteros, S Krugliansky
10/11/2022 - 14:00 a
15:30
Discusión de Posters Electrónicos 11
Gastroenterología y Nutrición 2
Columnas del
Boulevard
0036 LESION ESPLENICA SECUNDARIA A VIDEOCOLONOSCOPIA
A
Gira, R Almanza, P Falvo, D Monardo, P Pratesi, M Ugarte
0048 SINDROME COMPARTIMENTAL ABDOMINAL POR SARCOMA DEL ESTROMA ENDOMETRIAL
JJ
Madera, M Lanci, J Marchetti, C Hernandez, G Guerrero, N Grubissich, C Rollano,
T Negreira, H Cacone, J Aguilar, M Steinhaus, P Boschini
0119 ESOFAGO NEGRO EN PACIENTE CON POLITRAUMA Y SHOCK HIPOVOLEMICO
EJ
Gironacci, A Bianchi, MN Göldy, N Ortiz, E Gonzalez, I Gustavo, L Talamonti, SI
Sanchez, E Gonzalo
0149 PANCREATITIS AGUDA SEVERA POR HIPERTRIGLICERIDEMIA: PRESENTACIÓN
DE UN CASO Y SU TRATAMIENTO
M
Agosta, DH Gonzalez, M Curone, J Roque, J Etcheverria Trigo, F Pecoraro, L De
Bari, L Buira
MA
Alzugaray, S Izza, M Filippi, N Carrizo, R Avila
G
Cruz, C Caceres, M Balceda, M Lamas, V Gallardo, C Tintolay, D Sajama, P
Balceda, N Palacios, G Rodriguez, D Crespo, P Baez, O Lopez, V Limon
G
Rodriguez, N Palacios, M Lamas, P Balceda, V Gallardo, G Cruz, M Balceda, P
Baez, O Lopez, V Limon, C Tintilay, D Sajama, D Crespo
10/11/2022 - 14:00 a
15:30
Discusión de Posters Electrónicos 12
Infectología 2
Columnas del
Boulevard
AL
Ramirez Ayala, J Ripoll
0220 CRIPTOCOCOSIS MENÍNGEA EN PACIENTE CON USO CRONICO DE
CORTICOIDES: REPORTE DE CASO
OF
Ferreira Aban, CF Chavez, R Dominguez, J Cardozo, L Soliz, JC Galarza, MB
Vazquez, C Pozo, N Grubissich, D Pina
0224 NEUMONÍA EOSINOFÍLICA SECUNDARIA A DAPTOMICINA
SG
Pello, ML Ortiz, A Couso, AB Canedo Bermudez, SS Benavides Mariño, P Balmaceda,
MA Ducasa Torres, MF Amieva, V Picolla, GE Ramos, CB Cozzani
0235 REPORTE DE CASO DE PARACOCCIDIOIDOMICOSIS DISEMINADA
E
Cautures, V Torres, JI Ibarzabal, JC Pendino, FO Fiorilli, LR Bettini
0247 SHOCK SÉPTICO POR SÍNDROME DE LOEFFLER. REPORTE DE UN CASO
G
Gomez, ML Campassi, F Repetto, D Banegas, M Cuitiño, B Tiseyra, I Ramirez, L
Flores Trusso, C Fauez
0280 ENCEFALITIS HERPETICA CON TRANSFORMACION HEMORRAGICA: UNA
COMPLICACION MUY POCO FRECUENTE
L
Tumino, E Valgolio, MC Marchena, B Franco, I Zoilo, LE Baldaseroni, L Gatti, O
Rolon, S Eiguren, P Lucero, G Rolandelli, A Veitia, M Quiroga, M Girves
0281 CRIPTOCOCOSIS MENINGEA POR CRYPTOCOCCUS NEOFORMANS EN PACIENTE
INMUNOCOMPETENTE
Y
Lamberto, N Grecco, C Dominguez, R Gregori-sabelli, P Saul, N Chacon, C Susana,
F Messina, L Gonzalez, MDLM Nano, P Velezquez Lopez, E Cortez, V Chediack, E
Cunto
0283 EXPERIENCIA EN MALARIA GRAVE CON TERAPIAS CONTINUAS EXTRACORPOREAS.
REPORTE DE UN CASO
R
Gregori Sabelli, JM Fernandez, CV Dominguez, P Saul, N Chacon, Y Lamberto, G
Astudillo, A Bocassi, E Cortez, Y Huarachi, S Caceres, V Fernandez Arbelllo, V
Chediack, ER Cunto
0286 ENDOCARDITIS CON HEMOCULTIVOS NEGATVOS, REPORTE DE UN CASO DE
ENDOCARDITIS POR BARTONELLA SPP
E
Artigas, MA Flores Montes, C Molina, S Santillan, A Rodriguez, L De Vedia, E
Cunto
CA
Cimino, CF Pereyra, E Martinez, J Kenny, V Aranda, M Willig
10/11/2022 - 15:30 a
17:00
Discusión de Posters Electrónicos 13
Infectología 3
Columnas del
Boulevard
O
Martinez, MC Palacio, JC Medina, M Chamadoira, G Francini, N Aguilar, V
Murillo, J Camargo, F Avila, A Gutierrez, C Quintanilla, C Reyes, T Canabal, M
Beck
0129 MUCORMICOSIS RINORBITARIA: REPORTE DE UN CASO CLÍNICO
F
Cometto, L Luque Aguada, N Leonardia, M Garcia Keim, S Dipente, C Salcedo, G
Squaglia Acosta, RL Aguilera
I
Cruz Muñoz, AE Carrera, SD Riback, R Ostrowski, C Correia Dasilva, N Barreto, M
Arguello, M Pohlemann, AJ Alarcón Marinoni, D Acosta, L Santana, R Contreras, M
Rodriguez, M Kaechele
0168 HANTAVIRUS: REPORTE DE UN CASO
MM
Palacio, CA Eckhard Morales, E Avila
DP
Acosta, D Vazquez, N Fermin Paredes, W Rosales, C Bernal, S Eiguren, L Bucetta
M
Baron, P Schoon, L Benito, N Montaño, N Carbajal, P Anave, P Carrasco
0200 MENINGITIS TUBERCULOSA EN PACIENTE CON ETILISMO CRÓNICO
MN
Göldy, A Bianchi, J Gironacci, N Ortiz, E Gonzalez, R Martinez Oveid, G
Izaguirre, L Talamonti, S Sanchez, G Elías
0212 SINDROME CARDIOPULMONAR POR HANTAVIRUS. A PROPOSITO DE UN CASO
M
Paz, S Araoz, NB Pinello, NG Passo
N
Montaño, P Carrasco, P Schoon, L Benito, N Carbajal, P Anave, M Baron
10/11/2022 - 15:30 a
17:00
Discusión de Posters Electrónicos 14
Obstetricia
Columnas del
Boulevard
0030 ABDOMEN AGUDO DE ETIOLOGÍA POCO FRECUENTE EN EL PUERPERIO
M
Montenegro, P Okurzaty, MA Balauz, S Galceran
L
Juarez Gastiazoro, C Nestor Ivan, R Nadia, F Anabella, R Tamara, B Maria Luz, C
Leandro, H Marcos Emilio
0070 MANEJO MULTIDISCIPLINARIO EN GRAN QUEMADA EMBARAZADA
A
Regules Armiñana, E Ghisolfi, JM Pina, R Paffumi, A Chena, M Chocobar, L
Fernandez
E
Gonzalez, A Bianchi, N Göldy, N Ortiz, J Gironacci, A Borgherini, G Izaguirre,
L Talamonti, S Sanchez, G Elias
0166 USO DE ACIDO TRANEXAMICO EN PACIENTE CON ENFERMEDAD DE VON WILLEBRAND
CON SHOCK HEMORRAGICO
A
Gira, F Leveratto, V Pousa, A Riios, P Pratesi
0356 EVALUACIÓN DEL FLUJO UTERINO EN GESTANTE CON SHOCK CARDIOGÉNICO
BAJO SOPORTE ECMO
ML
Ojeda, L Perez, L Haddad, M Acebo, F Molina, D Otalora, C Ballesteros, L
Aguirre, F Klein
0362 MOTIVOS DE INGRESO
OBSTETRICOS EN TERAPIA INTENSIVA
MM
Barraza, GA Levy, RA Karatanasopuloz, AR Serruya, LV Gossen, MF Mendieta, JC
Flores, SA Gimenez Pedemonte, M Barrios D´ambra
0367 DIABETES INSIPIDA EN EL EMBARAZO
E
Hualpa Yucra, J Claros Ibañez, D Mariano Da Silva, N Navarro, A Salguero, G
Miglioretti, PG Gil, S Kulling, V Peregrina, N Varrenti, AK Marquez, F Campero,
A Alarcon, G Moreno
0407 SÍNDROME DE HIPERESTIMULACIÓN OVÁRICA, A PROPÓSITO DE UN CASO
D
Carpio, DI Carpio Celis, M Chavez, J Ortiz
10/11/2022 - 15:30 a
17:00
Discusión de Posters Electrónicos 15
Neumonología-Kinesiología 2
Columnas del
Boulevard
0020 INJURIA POR INHALACIÓN: SERIE DE CASOS SOBRE MANEJO BRONCOSCÓPICO
J
González Anaya, I Carboni Bisso, V Ruiz, F Rosciani, I Fernández Ceballos, M
Las Heras
JM
Nuñez Silveira, VR Ruiz, LN Borrajo, EM Steinberg, I Ceballos, J Ems, N Roux
VA
Gallardo, GV Limon, M Lamas, P Balceda, G Cruz, M Balceda, D Crespo, C
Tintilay, D Sajama, C Caceres, G Rodriguez, N Palacios, O Lopez, P Baez
0232 PREVALENCIA DE VENTILACIÓN MECÁNICA PROLONGADA EN PACIENTES CON
TEC GRAVE
MD
Bovetti Galván, DM Miqueri, LN Rodriguez, LM Ramirez, VA Medina, AM Caliva, FS
Flores
C
Parellada, GV Claro, KE Jakobsen, MJ Arias, J Fain, S Pellegrini, M Truszkowski
0250 INJURIA PULMONAR INDUCIDA POR PARAQUAT
VS
Iglesias, S Iturri, F Villarejo, P Damian, R Romina, P Jose, R Vitello
M
Carreño Mejia, V Reyes, A Flores, G Ponnefz, I Corgoglioni, M Manosperta., M
Ortega
J
Vilca, T Juhasz, C Loudet, F Iglesias, L Tumino, G Saenz, T Sahar, A Ortiz, F
Cornejo, F Alfonsin, ME Zmolnig
0285 TRAUMA LARÍNGEO EXTERNO SCHAEFER-FUHRMAN GRADO V: A PROPÓSITO DE
UN CASO
F
Puzzo, S Cagide, J Gómez, L Diaz Ballve
0393 PREVALENCIA DE DISFAGIA EN PACIENTES INTERNADOS EN UNIDAD DE
CUIDADOS INTENSIVOS
J Soria, M Singh, F
Am, J Moreno, S Ramos
10/11/2022 - 15:30 a
17:00
Discusión de Posters Electrónicos 16
Neurointensivismo 2
Columnas del
Boulevard
LJ
Ojeda Flores, K Velazquez, L Solis, M Gonzalez, LB Costa, C Pisarello, JE
Alfonso, J Bernachea, S Gamarra, V Gimenez, J Martinez, C Mizdraji, L Huespe, S
Lazzeri, H Alvarez
0132 FISTULA CAROTIDA-YUGULAR TRAUMÁTICA TARDIA. REPORTE DE CASO
A
Gutierrez, MC Palacio, JC Medina, M Chamadoira, G Francini, N Aguilar, V
Murillo, O Martinez, J Camargo, F Avila, C Reyes, C Quintanilla, T Canabal, M
Pataro
0157 SÍNDROME DE VASOCONSTRICCIÓN CEREBRAL REVERSIBLE: SERIE DE CASOS
MV
Gonzalez, CG Videla, NM Ciarrocchi, E San Román, JF Sinner
0169 VASOESPASMO POST CIRUGÍA DE RESECCIÓN DE ADENOMA HIPOFISARIO:
PRESENTACIÓN DE UN CASO
S Schverdfinger, C
Videla, N Ciarrocchi, J Sinner
NA
Issoglio, NI Carrizo, MM Filippi, MN Kinderknech, V Fugas
0231 PUNCIÓN TRANS-ORBITAL COMO MANIOBRA DE RESCATE
L Flores Trusso, ML
Campassi, F Repetto, D Banegas, G Gomez, B Tiseyra, I Ramírez, N Picard, C
Fauez
0248 HEMORRAGIA SUBARACNOIDEA COMPLICADA CON SINDORME DEL CORAZON ROTO
P
Spina, P Amancay, G Gimenez, L Iglesias, A Peñaloza, S Enzo, G Scuaglia
0304 SINDROME DE ONDINA
ADQUIRIDO. REPORTE DE UN CASO
E
Porjolovsky, EM Porjolovsky, P Cordero, L Pero, D Lafosse, A Tristaino, N Perez
Murua, K Cisneros, B Castro, L Franconieri
0314 EXACERBACION DE SINDROME DE YAO EN UNA PACIENTE NEUROCRITICA.
REPORTE DE UN CASO
RA
Ojeda, YM Lamberto, AC Dinuzzo, A Violo, DV Toledo, R Lobo Herrera, JA Sereno,
ME Centurion, MA Montenegro, LJ Degregorio, MC Carruega, PJ Marconi, MF Alsina,
EP Mikulic
0319 DIABETES ÍNSIPIDA CENTRAL EN HISTIOCITOSIS DE LANGERHANS
J
Quiroz Cedeño, G Monti, M Mansur, G Gaudenzi, M Rolando, K Banzer, O Ferrufino,
F Perez, D Parraga, K Gamarra, A Canchila, A Fernandez, A Gonzalez, D Mingoni
11/11/2022 - 14:00 a
15:30
Discusión de Posters Electrónicos 17
Infectología 4
Columnas del Boulevard
LA
Dulcey Sarmiento, JS Theran Leon, R Caltagirone, MJ Aguas Cantillo, F Rangel,
RG Parales Strauch, V Cabrera Peña, A Quintero Romero
0061 REPORTE DE CASOS: PIELONEFRITIS ENFISEMATOSA DEL HOSPITAL
SIMPLEMENTE EVITA
EM
Rodas Montero, G Izzo, M Flores, E Solarte, L Gonzales, A Vera, J Angulo, A
Rodriguez, H Cabrera, A Robles, C Arellano, E Rodriguez, E Velasquez, D Choque
0064 ENCEFALOPATÍA ESPONGIFORME TRANSMISIBLE HUMANA: REPORTE DE UN
CASO
J
Voss, A Aliaga, R Segovia, J Moreno, F Freile, L Rocha, N Muicela, N Tanel, D
Ullunque, A Ayarde, J Guillermina, A Luquetti, A Orozco, N Melina
0077 REPORTE DE CASO: BOTULISMO ALIMENTARIO CON PERFORACIÓN INTESTINAL
EN UNA ADOLESCENTE
SI
Ramos Elizagaray, ML Piovano
0080 BACTERIEMIA POR RHODOCOCCUS EN PACIENTE INMUNODEPRIMIDO
FR
Dipaolo, M Latimori, F Garavelli, M Ramirez Colombres, C Maenza, M Re, S Gattino,
N Rocchetti, C Settecase, D Bagilet
0087 MENINGITIS POR FEOHIFOMICOSIS EN PACIENTE CON TRASPLANTE DE
ORGANO SOLIDO
A
Gira, F Monsalve, D Czerwonko, P Falvo, D Monardo, P Pratesi
S
Gasparotti, LM Rodriguez, FP Bertoletti
0109 SEPSIS A SERRATIA MARCESCENS EN CIRUGIA PROGRAMADA (PRESENTACIÓN
DE CASO CLÍNICO)
ME
Olobardi, N Moscillo, L Iwanczyna, A Fernandez, AM Mazzola
0116 NEUMONÍA AGUDA DE LA COMUNIDAD POR STENOTROPHOMONA MALTOPHILA.
REPORTE DE UN CASO CLÍNICO
F
Cometto, M Jaime, O De Nardis, HA Trillard, M Binci Vayer, S Dipente, E Guzman,
G Martinez, M Ciarlantini
11/11/2022 - 14:00 a
15:30
Discusión de Posters Electrónicos 18
Covid 3
Columnas del
Boulevard
0118 COVID-19 Y ENCEFALITIS HERPÉTICA
M
Ramirez Colombres, CE Maenza, NS Rocchetti, SP Gattino, S Diodati, C Luchitta,
M Re, CJ Settecase, DH Bagilet
0120 ENFERMEDAD POR ANTICUERPOS ANTIMEMBRANA BASAL GLOMERULAR EN
PACIENTE CON COVID-19
M
Ramirez Colombres, CE Maenza, M Latimori, F Garavelli, F Dipaolo, M Re, SP
Gattino, NS Rocchetti, CJ Settecase, DH Bagilet
JA
Murtula Ferreyra, S Bernthal, J Bartoli, M Heredia, F Alvarez, M Guereschi, A
Muhlberger, G Martini, L Castillo, P Diaz, S Julia, D Morales, F Dominchin, A
Barcelo
0218 SINDROME INFLAMATORIO MULTISISTÉMICO EN EL ADULTO ASOCIADO A
COVID19
P
Boschero, M Acquafredda, G Tombolini, S Gonzalez
G
Rolandelli, I Petel, F Larocca, E Barone, D Vera
0246 COVID MULTISISTEMICO DEL ADULTO
M
Gardeazabal Rospilloso, MR Gardeazabal Rospilloso, J Vilca, I Parodi, M
Cordoba, A Cucci, F Morales, AL Piñas, L Tumino, C Loudet, A Toro
0320 REPORTE DE CASO: MENINGOENCEFALITIS ASOCIADA A COVID 19
G
Fernández, S Barrionuevo, V Cuéllar, H García, ME Giménez, R López, MM Tártara,
S Urbano, S Viera, R Vargas Martínez, L Migliacci
0333 MANEJO DE ESTENOSIS TRAQUEAL EN PACIENTES COVID-19
M Singh, F Am, J
Moreno
PG
Insaurralde, J Leiria, I Garcia, M Abbate, V Thomas, N Etchechoury, F Gonzales
11/11/2022 - 14:00 a
15:30
Discusión de Posters Electrónicos 19
Pediatría 2
Columnas del
Boulevard
J
Palmeiro, Y Nociti, V Laulhé, P Taffarel
C
Hajdinjak, A Fernandez, A Avila, S Palletti
0097 REPORTE DE CASO. MUCORMICOSIS GASTROINTESTINAL PEDIÁTRICO
NM
Valenzuela, MG Lafuente, MA Acuña
0117 REPORTE DE CASO. MIELITIS TRANSVERSA VS TRAUMA MEDULAR
NM
Valenzuela, MG Lafuente, MA Acuña
0134 TUBERCULOSIS NEONATAL CONGÉNITA DISEMINADA. A PROPÓSITO DE UN
CASO
J
Jonas, MM Reinares, J Manniello, MA Forchino, A Romagnoli, M Castilla, M
Allassia
E
Walter, PI Rossi
E
Walter, PI Rossi
0174 TUBERCULOSIS EXTRAPULMONAR EN LA TERAPIA INTENSIVA INFANTIL.
REPORTE DE CASO
M
Pazmino, M Gonzalez, P Castellani, C Lutkevicius, A Bordogna, M Rabino
M Helmfelt, M Picullo,
J Maniello
11/11/2022 - 14:00 a
15:30
Discusión de Posters Electrónicos 20
Trauma-Toxicología-Reumatología 1
Columnas del
Boulevard
F
Morales, M Córdova, A Cucci, M Gardeazabal, I Parodi, C Logiodice, J Villca, F
Fernández Garcia, L Milanesio, F Iglesias, A Carrera, G Saenz, A Toro, L
Tumino, CI Loudet
0237 SINDROME CATATONICO: UN DESAFIO PARA LAS UNIDADES CRITICAS. A
PROPOSITO DE UN CASO
I
Petel, M Steinberg, M Cozzi, MA Barrientos, D Vera
M
Montenegro, MC Vignetta, P Pahnke, E Dantur, G Solla, AO Ohanian, M Crespo, A
Fabre, A Storniolo Squintone, D Dib, A Lopez, I Herrero, I Ocampo, V Vignolo
0345 SÍNDROME NEUROLÉPTICO MALIGNO REPORTE DE CASO CLÍNICO
L
Ruarte, L Morales, M Garcia, P Taborda, J Ortega, A Quinteros, S Rojas, C
Ferreyra, D Carranza, N Bonetto, S Carrizo, J Celia, M Ruiz, M Buemo
DA
Otálora Lozano, LC Pérez, MA Acebo Acha, LY Haddad, FA Molina Jiménez, L Ojeda,
RA Noreña, S Finoli, L Aguirre, F Klein
AJ
Alarcon Marinoni, C Farqhuarson, S Ribak, AE , M Pohlemann, M Argüello, D
Acosta, M Kaechele, N Barreto, R Otrowski, V Romina
0370 SOPORTE EXTRACORPOREO EN TANDEM. REPORTE DE CASO
E
Manrique, J Bernasconi, Y Lombi, R Avila
0372 INTOXICACIÓN CRÓNICA DE PLOMO POR HERIDA DE ARMA DE FUEGO
BF
Acosta Torres, JP Klein, F Condori
0374 RETIRO DE SOPORTE VITAL. EXTUBACIÒN TERMINAL EN PACIENTE CRÌTICO
M
Bezzati, A Martinez
0394 DISFUNCIÓN ORGÁNICA
SECUNDARIA A CONSUMO DE MDMA
I
Peña Cecconi, Y Saad, R Arevillca Yugar, J Navia, LM Castiblanco, K Botana
11/11/2022 - 15:30 a
17:00
Discusión de Posters Electrónicos 21
Shock y Sepsis
Columnas del
Boulevard
0065 SHOCK ANAFILACTICO CONFIRMADO POR MEDICION DE TRIPTASA SERICA
SERIADA
A
Gira, M Cardonati, F Leveratto, J Alvarez, P Pratesi
AB
Rojas, S Chaile, M Dextre Primo, F Castro, D Reynoso, M Andreotti, JC
Vergottini
0145 ESTIMACIÓN DEL VOLUMEN PLASMÁTICO Y MORTALIDAD POR SEPSIS EN
UNIDAD DE CUIDADOS CRÍTICOS
MC
Pohlemann Tarnovski, S Ribak, E Carrera, A Villalba, C Farquharson, N Barreto,
A Matías, R Villalba, M Kaechele, A Alarcón, D Acosta, C Correia
0186 LOXOSCELISMO SISTEMICO: REPORTE DE UN CASO CLINICO
N
Carbajal, P Carrasco, P Schoon, L Benito, N Montaño, M Baron, P Anave, D Suster
S
Bernthal, J Bartoli, M Guereschi, F álvarez, M Heredia, A Muhlberger, J Múrtula
Ferreyra, G Martini
0226 SINDROME DE WUNDERLICH, UNA CAUSA POCO COMÚN DE SHOCK: REPORTE DE
UN CASO
L
Soliz, J Cardozo, R Dominguez, MB Vazquez, C Chavez, F Ferreira, JC Galarza, C
Pozo, N Grubissich, D Pina
J
Quiroz Cedeño, G Monti, G Gaudenzi, P Verta, M Rolando, K Banzer, O Ferrufino,
M Mansur, F Perez, D Parraga, K Gamarra, A Canchila, A Fernandez, A Gonzalez, D
Mingoni
LC
Avila, M Martinez, G Abrile, E Rodriguez
J
Bernachea, V Giménez, L Gamarra, J Martinez, L Ojeda, C Mizdraji, S Lazzeri, E
Alfonso, H álvarez, L Costa, C Pisarello, L Huespe, K Velazco, L Solis, M
Gonzalez
R
Ronchi, O Ortiz, MS Ríos, D Murillo, L Vargas Ruiz, K Tapia Alvarez, S
Fernández, L Tumino, MG Sáenz, C Loudet
0408 FALLA MULTIORGANICA DE ETIOLOGIA POCO FRECUENTE
MA
Misa, DC Rodriguez, CL Landoni, A Brañez Toro Yasmani, A Luzzi, C Plaza, S
Markevich, S Roldan Montaño, J Vazquez, A Brizuela, JP Soliz
11/11/2022 - 15:30 a
17:00
Discusión de Posters Electrónicos 22
Trasplante
Columnas del
Boulevard
L
Bujan Molins, LS Maidana, JF Paucar Paucar, SD Villarroel Medonza, SE Giannasi
0079 ESTENOSIS BILIAR EN EL POSTOPERATORIO DE TRASPLANTE HEPÁTICO
SS
Benavides Mariño, MF Amieva, G Ramos, C Tonelli, M Ducasa, CB Cozzani, V
Picolla, A Couso, AB Canedo Bermudez, ML Ortiz, SG Pello
DA
Rodriguez, P Centeno, M Petre, R Canelon, L Boffino, L Sanabria, E Montiel, M
Anchorena
I
Fernández Ceballos, E Steniberg, JM Nuñez Silveira, J Ems, M Madormo, I Carboni
Bisso, MJ Las Heras, JF Sinner
N
Fermin
C
Pisarello, JE Alfonso, H Alvarez, EA Fernandez Da Veiga, MR Sanabria, R Garcia,
V Lezcano, L Fernandez, M Dickau, LB Costa, S Doval, A Ramirez, A Ruiz Diaz
0339 TRASPLANTE HEPATICO (TXH) EN HÍGADO GRASO AGUDO DEL EMBARAZO
(AFLP). REPORTE DE CASO.
F
Molina, L Perez, L Ojeda, L Haddad, M Acebo, D Otalora, G Tuhay, C Ballesteros,
G Pantoja, F Klein
0353 DISFUNCIÓN PRIMARIA DE INJERTO HEPÁTICO: REPORTE DE UN CASO
DG
Sanchez
M
Acebo Acha
LY
Haddad, L Perez, F Molina, M Acebo, L Ojeda, D Otálora, C Ballesteros, G
Pantoja, L Aguirre, F Klein
A
Bárbara, P Reyes, MH Fernández Darritchon, P Longo, AJ Siaba Serrate, S Torres,
T Iolster
11/11/2022 - 15:30 a
17:00
Discusión de Posters Electrónicos 23
Neurointensivismo 3
Columnas del
Boulevard
L
Corbalan, C Vignetta
0338 TROMBOSIS VENOSA CEREBRAL UN RETO DIAGNÓSTICO Y TERAPÉUTICO.
REPORTE DE CASO
CSA
Cieri, C Lopez, M Vera, D Aldunate, G Chiarolla, S Santarelli, G Fernandez, H
Vitale, A Ontiveros, A Sabrina
0340 SINDROME DE HIPERVISCOSIDAD EN PACIENTE CON MACROGLOBULINEMIA DE WALDESTROM
A
Gira, F Monsalve, R Almanza, A Perez De Andes, C Steer, P Pratesi, G Mast
0351 INDICACIÓN DE BIOPSIA ESTEREOTÁXICA EN DIAGNÓSTICO DE HEMORRAGIA
INTRACEREBRAL ESPONTÁNEA
M
Villalobos, E Quispe, Á Vélez, R Méndez, A Guarachi, M Altamirano, S Pérez, M
Mendoza, J Campos, J Condori, A Pedrazas, J Quispe, P Villalobos
0381 HEMORRAGIA SUBARACNOIDEA EN PACIENTES ONCOHEMATOLÓGICOS. REPORTE
DE CASO
R
Arevillca, P Gomez
AS
Piga, TE Lujan, CS Senger
R
Retambay, RR Reinoso, NS Llanes
0392 TROMBOSIS VENOSA CEREBRAL CON TRANSFORMACION HEMORRAGICA EN
ENFERMEDAD DE WILSON
L
Castiblanco
R
Arevillca
0401 PRESENTACIÓN ATÍPICA DE UN CASO DE GUILLAIN BARRE POSVACUNACIÓN
M
Teherán, G Rodrigues, D Santos, S Toledo, J García
11/11/2022 - 15:30 a
17:00
Discusión de Posters Electrónicos 24
Trauma-Toxicología-Reumatología 2
Columnas del
Boulevard
VP
Lobo, M Isa, JE Perez Romero, RA Dilaccio
0094 A PROPOSITO DE UN CASO INFRECUENTE DE SINDROME SEROTONINERGICO
S
Quintana, D Barrientos, J Cardozo, F Arancibia, A Rodriguez, N Montaño, D
Romero, R Altamirano, G Rodriguez, W Videtta, A Tamayo, T Huanca, A Barra
Montes De Oca
0103 SINDROME ANTIFOSFOLIPIDICO CATASTROFICO. A PROPOSITO DE UN CASO
M
Cordoba, A Cucci, F Morales, M Gardeazabal, I Parodi, C Logiodice, J Vilca
Becerra, F Fernandez, ML Gutiérrez, A Paglia, L Tumino, F Iglesias, C Loudet, A
Testi
MM
Kaechele, M Arguello, R Villalba, M Pohlemann, D Acosta, A Alarcon, R Ostrowski,
A Carrera, S Ribak, C Farquharson, N Barreto
0135 PRESENTACION ATIPICA DE HIPERTIROIDISMO EN PACIENTE CRITICO:
PRESENTACION DE UN CASO
L
Doldan, M Galindo, C Vargas, C Dominguez, R Gregori, Y Lamberto, P Saul, N
Chacon, V Chediack, E Cunto
0144 INTOXICACIÓN CON ÁCIDO VALPROICO: REPORTE DE CASOS
L
Morales, P Pahnke, A Vilkelis
0188 FALLA MULTIORGÁNICA DEBIDA A MORDEDURAS MÚLTIPLES DE ARACNIDOS
S
Ruiz Laos, J Morales Corvacho
0217 ENFERMEDAD DE POMPE, ENFERMEDAD RARA DEL ALMACENAMIENTO DE
GLUCOGENO
P
Zuleta Chambi, A Bonilla, E Polo, J
Rivadeneira
0249 PACIENTE JOVEN CON MICROAGIOPATIA TROMBÓTICA INDUCIDA POR SEPSIS
F
Garavelli, M Re, N Rocchetti, F Di Paolo, M Latimori, M Ramirez Colombres, C
Maenza, S Gattino, C Settecase, D Bagilet
PREMIOS
09/11/2022 - 08:00 a
09:00
Orales Premios 01
Premio 1
Las Américas
0034 LA GRAVEDAD DEL SDRA INTERFIERE CON EL VALOR CLÍNICO DE LA POTENCIA
MECÁNICA
N
Pistillo, P Castelluccio, I Suzuki
G
Plotnikow, FJ Bianchini, RS Moracci, FJ Gutierrez, JA Santana Mackinlay, F
Melgarejo, MP Loustau, V Acevedo, E Di Salvo, J Mariani
I
González, CB Dominguez, EA Di Salvo, MP Loustau, VS Acevedo, JC Melero, MD
Celano, FJ Bianchini, FJ Gutierrez, J Mariani, G Murias, GA Plotnikow
GA
Plotnikow, DS Villalba, E Perez Calvo, C Quiroga, E Navarro, E Gogniat
M
Accoce, J Pérez, J Dorado, D Gilgado, G Cardoso, M Bertozzi, A Vitale, C
Papazian, M Calvo Delfino, C Snaider, R Bragagnolo
09/11/2022 - 13:00 a
14:00
Orales Premios 02
Premio 2
Las Américas
I
Carboni Bisso, D ávila Poletti, A Massó, E Prado, JM Nuñez Silveira, E Sosa, P
Buchanan, R Aimé, V Richter, M Buscaglia, MR Risk, J Sinner, M Las Heras, I
Huespe
D Moretti, CA
Luchitta, DH Bagilet, NS Rocchetti, SP Gattino, MD Ré, S Diodati, CJ Settecase
M
Busico, NA Fuentes, A Gallardo, A Vitali, J Quintana, M Olmos, M Esperatti
I
Gavilan, J Figueredo, C Figueredo, L Fontclara, AM Ferreira, N Crosta, LM
Pederzani, H Bianco, F Ferreira, B Figueredo
M
Esperatti, NA Fuentes, M Busico, M Olmos, A Gallardo, A Vitali, H Kakisu, J
Quintana, A Lagazio, S Saavedra, A Miranda, ME Gonzalez, M Mogadouro, ACG High
Flow And Prone Positioning
J
Pérez, JH Dorado, E Navarro, DI Gilgado, GP Cardoso, I Telias, PO Rodriguez, M
Accoce, L Brochard
10/11/2022 - 08:00 a
09:00
Orales Premios 03
Premio 3
Atlántico B
KM
Manzur, ADLM Manzur
I
Lockhart, I Huespe, C Lockhart, F Pálizas Jr, M Colombo, MDP Romero, E Prado, C
Casabella García, M Las Heras, I Carboni Bisso
M
Castillo Ortega, FA Sosa, J Weight, A Matarrese, JJ Ruiz, G Paz, J Osatnik, M
Kleinert, G Cesar, D Ivulich, P Merlo
D
Villalba, E Navarro, A Matesa, A Brusco, V Morales, GG Morel Vulliez, E Rositi,
L Prieto, M Bosso, S De Paoli, A Cotero, J Nadur, M Santini, M Alonso, F
Larroca, C Duarte, V Garcia, R Campodónico, G Musso, M Leingruber, A Morales, A
Segura, ME Vallory, S Pieruzzi, P Pascal, EL De Vito
A
Vicente, D Villalba, L Diaz Ballvé, P Pedace, E Perez Calvo, P Tocalini, JM
Carballo, K Torres, G Petraroia, J Collins, A Matesa, G Gil Rossetti, N
Golfarini, P Pini, L áreas, A Del Valle, M Scrigna, E Distefano, F Planells
D
Vasquez, R Giannoni, A Salvatierra, K Cisneros, D Lafosse, F Escobar, M
Montenegro, P Juárez, L Visani, V Mandich, E Barrozo, M Kirschbaum, A Das
Neves, MF Valenti, MC Canseco, I Romero, P Macharé, A Marquez, E Rodriguez, C
Palacio, L Rapela, J Amillategui Scenna, R Nuñez, S Torres, G Plotnikow, MA
Gonzalez, L Franconieri, D Nasner, P Okurzaty, AD Intile
10/11/2022 - 13:00 a
14:00
Orales Premios 04
Premio 4
Atlántico B
0018 ÁCIDO TRANEXÁMICO EN TRAUMATISMO DE CRÁNEO LEVE Y MODERADO CON
LESIÓN TOMOGRÁFICA
ME Blessio, PB Pahnke,
I Puig
AD Bujedo, MC
Vignetta, PB Pahnke
0052 EVALUACIÓN DE LA DISFUNCIÓN VENTRICULAR DERECHA EN PACIENTES
SÉPTICOS
L
Bertorello Andrade, A Sosa, A Matarrese, F Daldoss, G Yossa
R
Talma, T Robetto
0202 MIOCARDIOPATÍA SÉPTICA: UTILIDAD DIAGNÓSTICA DEL STRAIN
LONGITUDINAL GLOBAL
F
Daldoss, A Sosa, A Matarrese, BA Lucía, Y Giuliano
F
Scarselletta, L González, C Rios, S Lucini, C Sfara, N Díaz, L Zubeldía
Brenner, G Vinicoff, J Farina, S Esposto, F Gil
11/11/2022 - 08:00 a
09:00
Orales Premios 05
Premio 5
Las Américas
R
Fernandez, F Alvarez
CE
Maenza, NS Rocchetti, M Ramírez Colombres, M Latimori, FR Dipaolo, F Garavelli,
SP Gattino, MD Ré, CJ Settecase, DH Bagilet
JF
Caminos Eguillor, G Ferrara, MG Buscetti, VS Kanoore Edul, HS Canales, B
Lattanzio, L Gatti, FJ Gutierrez, A Dubin
A Senger, R Benitez, S
Amelia, S Altemburger
PN
Rubatto Birri, R Giannoni, M Furche, M Nahra, MG Arce Gallardo, G Segui, G
Tuhay, P Birri, M Romano, M Humacata, V Petrochelli, L Huespe, D Banegas, A
Gomez, G Zakalik, F Lipovesky, P Montefiore, C Galleti, J Pendino, M Vera, S
Mare, L Bergallo, G Fernandez, ML Campassi, F Rios
AM
Antón, R Giannoni, MG Arce, IS Gonzalez Pompilio, V Jozami, FF Giannoni, RO
Marañon
11/11/2022 - 13:00 a
14:00
Orales Premios 06
Premio 6
Las Américas
0076 BOTULISMO DEL LACTANTE: ESTUDIO DESCRIPTIVO EN UNA UNIDAD DE
CUIDADOS INTENSIVOS PEDIÁTRICOS
C
Avila, G Kaltenbach, MM Cardenas
0104 COMPLEJIDAD DE PRESIÓN INTRACRANEANA COMO SUBROGANTE DE
COMPLACENCIA CEREBRAL
N
Ciarrocchi, C Videla, S Hem, MDC Garcia, F Goldenberg, A Mansour, C Lazaridis,
F Pose, F Redelico
N
Ciarrocchi, C Videla, F Pose, S Hem, MDC Garcia, F Goldenberg, A Mansour, N
Issa, C Lazaridis, F Redelico
0245 CRANIECTOMÍA DESCOMPRESIVA PRIMARIA EN TRAUMATISMO
CRANEOENCEFÁLICO GRAVE
F
Garavelli, M Re, N Rocchetti, F Di Paolo, M Latimori, M Ramirez Colombres, C
Maenza, S Gattino, C Settecase, D Bagilet, J Meoli
RESÚMENES
R Fernandez(1), F
Alvarez(1)
(1) Español De Mendoza.
Introducción: En Argentina, según censo 2010, la población
≥ 65 años constituía el 10,2%, ubicando a nuestro país entre los más envejecidos
de la región.Es probable que los sistemas de salud, no se ajusten a las
demandas impuestas por la atención creciente de adultos mayores; no existiendo
según nuestro conocimientos, datos publicados que describan esta población,
características y evolución en relación a los Cuidados Intensivos.
Objetivo: Determinar prevalencia de pacientes añosos y
muy añosos admitidos en UCI y describir sus características y evolución.
Materiales y método: Estudio observacional, retrospectivo con
análisis secundario de base de datos SATI-Q entre 2011 y 2019. Se definió según
O.M.S. pacientes añosos entre 75 y 90 años y muy añosos a los >90 años. Se
extrajeron variables demográficas, clínicas, uso de dispositivos,
complicaciones y evolución.
Las variables cuantitativas se expresan como
mediana y RIC y se analizaron con U de Mann Whitney; las cualitativas se
expresan en frecuencias, porcentajes y OR. Fueron analizadas mediante test de
chi2 o chi2 para tendencias
En análisis post hoc se construyó un modelo
de regresión logística tomando como variable dependiente “Resultado
(Fallecido)”.
Se consideró significación estadística P
≥0,05.
Resultados: Entre 2011 y 2019 se registraron, 28.625
casos (19,8%) de ≥ 75 años y 2.037 (1,4%) > de 90. El porcentaje de
pacientes añosos se eleva de 15,7% en 2011 a 21,9% en 2019 y el de muy añosos,
de 1,3% en 2011 a 2,2% en 2019; p = 0,0001. Las características generales se
resumen en tabla1.
Las tasas de uso de dispositivos fueron de
43% para CVC 73,4% para SV y 41,9% ARM.
La tabla 2 muestra las características de los
pacientes sobrevivientes y fallecidos.
El análisis multivariado, mostró como
factores independientes de mortalidad edad, APACHE II, TISS 28 durante la
internación, uso de ARM, patología médica o trauma y dependencia de atención
pública.
Conclusiones: El porcentaje de pacientes añosos y muy
añosos asistidos en UCI aumentó en los últimos años de manera sostenida,
registrándose un uso importante de medidas de soporte vital, complicaciones
derivadas de las mismas y estadías prolongadas; esto podría generar a futuro un
fuerte impacto sobre el sistema de salud.


0002 TROMBOSIS VENOSA CEREBRAL:
VARON JOVEN
E Simes(1)
(1) Instituto Medico Quirurgico Mercado Luna.
Introducción: La trombosis venosa cerebral (TVC), es una enfermedad
cerebro vascular, muy poco frecuente, que se incluye dentro del grupo de
trombosis en sitios infrecuentes, afecta fundamentalmente a niños y mujeres en
edad fértil.
Caso clínico: Varon de 40 años de edad que presenta de
forma subita cefalea y afasia de expresión acompañado de paresia
braquio-crural. Evoluvionando con depresion del sensorio , trastorno
deglutorio. Se realizo anticoagulacion con heparinas de bajo peso molecular,
las primeras 24 horas , presentando hematoma intracerebral, por lo cual se
suspende . Luego de 15 dias de evolucion en UTI se otorga el pase a sala con
posterior antigoagulacion por presentar Trombosis en RM de control.
Laboratorios: colagenograma, complemento,
proteinas C y S normales, continauando control por hematologia.
TC sin contraste: signo del seno hiperdenso y
de la cuerda, hematoma. Los hallazgos descritos sugieren infarto venoso
cerebral con transformación hemorrágica. RM: vacio de flujo.
Conclusión: La TVP es una entidad poco frecuente pero
grave, que afecta sobre todo a gente joven. Es indispensable un diagnóstico
precoz TVC como las alteraciones parenquimatosas derivadas de ella son
potencialmente reversibles. La TVC tiene una presentación inespecífica y por lo
tanto es importante sospecharla ante resultados sutiles de imágenes y signos
indirectos que puedan indicarnos la presencia de trombosis.


0003 ENCEFALITIS
DESMIELINIZANTE AGUDA (EDA)
E Simes(1), N
Llanos(1), C Fernandez(1)
(1) Instituto Medico Quirurgico Mercado Luna.
Las enfermedades desmielinizantes son
aquellas en las que el proceso patogénico principal está dirigido contra la
mielina . Produciéndose una inflamación y/o destrucción selectiva de la misma.
El origen de las vainas de mielina que
envuelven los axones, provienen de distintos tipos de células gliales según se
localicen en el sistema nervioso central (S.N.C) o periférico (S.N.P).
Caso clínico: varon 37 años ingresa por paresia de los 4
miembros a predominio distal, vomitos, vertigo y trastornos deglutorios que rapidamente
evoluciona con insuficiencia respiratoria requiere ARM, con antecedentes de 25
dias anteriores fue vacunado contra covid 19, se relaiza PL , anticuerpos ACRA,
vitamina B12 , colagenograma completo , anticuerpos para covid, todo con
resultados normales, anticuerpos para vacuna covid positivos. RMN alteración de
intensidad de señal en ambos pedúnculos cerebelosos, protuberancia, tronco
cerebral con mayor afectación de su margen lateral derecho, pedúnculo cerebral
derecho y áreas con cambio de intensidad de señal vecinos a la región
subfalcina derecha y la región subependimaria y peritalámica izquierda,
alteración se interpretan secundarios a un trastorno de mielinización.
Se inicio tratamiento con corticoides e
inmunoglobulinas , presentando intercurrencias infecciosas por ARM prolongado ,
traqueotomia percutanea , luego de 55 dias de internacion se logra pase a
clinica , con recuperacion de furza muscular, vigil , sin trastornos de la
conciencia . Se controla al mes , donde presenta buena evolucion con
esuperacion de deglucion y fuerza muscular .
Conclusión: La EDA se caracteriza por una respuesta
autoinmune, que aparecerá tras una infección; reacción alérgica o
post-inmunización.Se considera que existe una sensibilización de linfocitos
contra el tejido encefálico debido a una reacción cruzada entre antígenos
infecciosos o agentes de inmunización y antígenos cerebrales, esto produce una
repuesta inflamatoria directa que compromete la sustancia blanca del SNC.


V Ruiz(1), F
Rosciani(1), I Carboni Bisso(1), I Fernandez Ceballos(1), M Las Heras(1), C
Lockhart(1), J Cantos(1)
(1) Hospital Italiano De Buenos Aires.
Objetivo: Evaluación de la eficacia y las
complicaciones asociadas con la realización de una traqueotomía percutánea (TP)
guiada por broncoscopia en pacientes con COVID-19.
Métodos: Estudio observacional, prospectivo, realizado
entre marzo de 2020 y febrero de 2022. Se incluyeron todos los pacientes
adultos a los que se les realizó TP guiada por broncoscopia electiva.
La eficacia del procedimiento se evaluó en
función de la tasa de éxito en la ejecución o en la necesidad de conversión a
técnica abierta. Además, se registraron las complicaciones tempranas y tardías.
Se compararon los resultados de pacientes con COVID-19 vs los pacientes sin
COVID-19.
Resultados: Durante el período de estudio se analizaron
312 TP guiadas por broncoscopia. 183 se realizaron en pacientes con COVID-19 y
129 en pacientes sin COVID-19. En general, el 64,1% (200) de los pacientes eran
del sexo masculino, con una mediana de edad de 66 (RIC 54 - 74) y el 65% (205)
presentaba al menos una comorbilidad.
En general, la desaturación fue la principal
complicación observada (20,8% [65]), siendo más frecuente en el grupo COVID-19
en un 27,3% (50) con una diferencia estadísticamente significativa vs el grupo
de pacientes no COVID-19 (11,6 % [25]); p<0,01).
Las complicaciones mayores como hipotensión,
arritmias y neumotórax también se observaron con mayor frecuencia entre los
pacientes con COVID-19, pero sin diferencias significativas. La TP se pudo
realizar de forma rápida y satisfactoria en todos los pacientes sin necesidad
de conversión a la técnica abierta. Asimismo, no se requirió en ningún caso la
suspensión del procedimiento.
Conclusión: La TP guiada por broncoscopia puede
considerarse un procedimiento eficaz y seguro en pacientes con COVID-19. Sin
embargo, es destacable que en la serie en estudio, un gran número de pacientes
con COVID-19 presentaron desaturación durante el procedimiento.

J Palmeiro(1), Y
Nociti(1), V Laulhé(1), P Taffarel(1)
(1) Elizalde.
Introducción: La práctica del kinesiólogo en la unidad de
cuidados intensivos pediátricos (UCIP) tiene un amplio campo de acción. Dentro
de sus incumbencias se encuentra la participación en el proceso de
desvinculación de la ventilación mecánica (VM). La implementación de un
protocolo para este proceso, evita la variabilidad en el abordaje y mejora los
indicadores en salud.
Objetivos: Determinar la práctica habitual del
kinesiólogo en el proceso de desvinculación de la VM invasiva (VMI) en las
UCIPs de Argentina.
Mensurar la utilización de protocolos para la
desvinculación de la VM y describir el tipo de prueba predominante.
Material y métodos: Estudio descriptivo, transversal,
multicéntrico, realizado a través de encuestas.
Resultados: Se contactaron 82 UCIPs de diversas áreas
geográficas del territorio Argentino, dos de las cuales manifestaron no contar
con kinesiología en la unidad. Se enviaron encuestas a través de Google Form a
80 UCIPs, las que respondieron en su totalidad. El 32,5% (N=26) utilizan un
protocolo para el proceso de desvinculación de la VMI. El 75% (N=60) de los
kinesiólogos encuestados manifiesta participar siempre o casi siempre de las
decisiones y acciones que se ejecutan en el proceso de desvinculación de la VM.
Se pesquisó asimismo las prácticas y mediciones que realiza el kinesiólogo, la
cantidad de camas por unidad y la relación camas/kinesiólogo, observándose en
esta última que un 35% de las unidades excede la recomendación que surge de la
Resolución 747/2014 del Ministerio de Salud de la Nación.
El 57,5% (N=46) de las UCIPs utiliza como
principal prueba de ventilación espontánea (PVE) la presión positiva continúa
con presión de soporte (CPAP/PS).
Conclusión: Existe un bajo porcentaje de protocolización
en la práctica habitual del proceso de desvinculación de la VM en pediatría.
Con alta participación del kinesiólogo, siendo la CPAP/PS el método de primera
elección para la PVE.
Palabras clave:
Kinesiología crítica pediátrica, destete de
ventilación mecánica, protocolización.
0009 Viabilidad del
posicionamiento en decúbito prono con un único operador: descripción técnica
A Masso(1), N
Gemelli(1), G Sotera(2), C Barrios(1), D Pina(2), I Carboni Bisso(1), M Las
Heras(1)
(1) Hospital Italiano. (2) Sanatorio
Franchin.
Objetivo: Determinar la viabilidad de la maniobra de
prono con un solo operador en pacientes síndrome de distrés respiratorio agudo
(SDRA) por COVID-19.
Métodos: Estudio retrospectivo, observacional y
unicéntrico, realizado entre marzo de 2020 y 2021. Se incluyeron aquellos
pacientes COVID-19 con SDRA en los que el posicionamiento en decúbito prono se
realizó con un solo operador.
La maniobra aplicada consta de 3 etapas:
Preparación:
Asegurar identificación del paciente e
indicación de ventilación en decúbito prono.
Realizar higiene general y oral.
Aspiran secreciones.
Corroborar la correcta fijación del tubo
orotraqueal.
Corroborar la correcta insuflación del balón de neumotaponamiento.
Suspender la alimentación enteral.
Asegurar medidas de seguridad
correspondientes al cuidado de sondas y catéteres.
Movilización:
Ubicar al paciente hacia un extremo de la
cama, movilizando en primer lugar los miembros inferiores y posteriormente
pelvis, torso, hombros y cabeza, respectivamente.
Cruzar las piernas.
El brazo opuesto al operador debe ser
colocado por debajo del paciente.
Colocar una almohada debajo del hombro del
paciente.
Retirar los elementos de monitoreo.
Rotar al paciente 90° hacia el lado libre de
la cama.
Jalar suavemente de la almohada debajo del
hombro, acompañando el movimiento de rotación.
Prestar especial atención a la vía central y
al tubo orotraqueal.
Cuidados post-movilización:
Recolocar los elementos de monitoreo y
chequear los signos vitales.
Aplicar silicona en zonas de apoyo para
evitar lesiones por presión.
Realizar una nueva maniobra de aspiración de
secreciones.
Resultados: Se analizaron los resultados 19 pacientes, 14
de sexo masculino, con una mediana de edad de 59 años y un índice de masa
corporal de 29. Cada paciente requirió entre 2 y 3 ciclos de prono, registrando
un total de 41 movilizaciones.
Un paciente presentó desplazamiento de sonda
nasogástrica, y en 2 casos se requirió más de un operador para completar la
movilización. No se registraron complicaciones tales como extubación, o retiro
accidental de accesos venosos.
Conclusión: Describimos la viabilidad del posicionamiento
en decúbito prono con un solo operador. A pesar de no registrar complicaciones
mayores tales como extubación o retiro accidental de accesos, se necesitan más
estudios para determinar la seguridad y utilidad de esta maniobra.

G Musso(1), M
Mangó(1), MC Gomez(1), G Appendino(1), L Friscione(2), C Gonzalez(1), C
Capitaine Funes(1), F Piatti(1), C Lovesio(1)
(1) Sanatorio Parque. (2) Instituto
Cardiovascular De Rosario.
Introducción: La traqueostomía (TQT) es el procedimiento
quirúrgico más frecuentemente realizado en pacientes COVID-19. La tasa de
supervivencia y decanulación en Argentina se desconoce. El objetivo principal
de este estudio fue evaluar la mortalidad y la tasa de decanulación al día 90
de realizada la TQT percutánea. Secundariamente se evaluó la tasa de lesión en
la vía aérea, días de ventilación mecánica invasiva (VMI) y días de internación
en unidad de cuidados intensivos (UCI).
Métodos: Estudio observacional analítico de cohorte
prospectiva que incluyó pacientes mayores de 18 años infectados por SARS-CoV-2
ingresados de forma consecutiva a la UCI con requerimiento de VMI y TQT
percutánea en el periodo comprendido entre 1 de febrero al 31 de julio del
2021.
Resultados: La mortalidad fue del 66.3%. De los
supervivientes se logró decanular al 67%. Los supervivientes fueron más jóvenes
[media 50.6 (DE 10.2) años versus media 58.9 (DE 13.4) años; p=0.001] y
presentaron puntajes más bajos de índice de Charlson [mediana 1 (RIQ 0-2)
versus 2 (1-3) puntos; p = 0.007]. Los pacientes TQT antes del día 10 desde el
inicio de VMI tuvieron menos días de VMI y menor estadía en UCI, p<0.01 y
p=0.01 respectivamente. El índice de Charlson se identificó como factor
independiente de mortalidad a los 90 días y de decanulación a los 90 días.
Discusión: En nuestra cohorte de pacientes fueron los
más jóvenes y con menos comorbilidades los que se beneficiaron con la TQT. El
índice de Charlson podría utilizarse como marcador pronóstico en esta población
de pacientes.
A Guzzetti(1), P
Zielinksi(1), M Teheran Wilches(1), L Pulido Blanco(1), C Basañes(1), L Rocha
Rivarola(1), F Allalla(1), A Savia(1)
(1) San Juan De Dios.
Introducció: La Fibrilación Auricular(FA) es un motivo de
consulta cada vez más frecuente a los departamentos de emergencia (DE) también
suele ser un epifenómeno en otras patologías agudas.
Objetivo: Describir las características de los
pacientes que consultan por FA como causa primaria a un departamento de
emergencias hospitalario.
Material y Método: Estudio descriptivo, retrospectivo de corte
transversal. Criterios de inclusión: Edad >16años, FA constatada en ECG de
guardia que consultaron al DE del Hospital San Juan de Dios Ramos Mejía entre
el 1/1/2019 y el 1/1/2022 por palpitaciones, taquicardia, arritmia, FA o
diagnóstico de egreso FA. Los datos se obtuvieron del sistema de HC. Se
transfirieron a Excel y se analizaron con Medcalc.
Resultados: Se identificaron 138 consultas. 70
femenino(51%) y 68 masculinos(49%). Promedio de edad 66 años [30-99]. FA
conocida en 77(56%) y detectada en guardia en 61(44%). Frecuencia ventricular
promedio fue de 118lpm [44-205]. Presentaron Falla hemodinámica – Insuficiencia
Cardiaca descompensada – Dolor Precordial – Deterioro del sensorio 22
pacientes(16%); 116 pacientes(84%) presentaron síntomas leves/moderados.
101(73%) presentaban patología concomitante(PC), 37 (27%) no presentaban PC.
Detalle PC: 46%,infecciosa, 19% vascular, sangrado 11%, otras 24%. Disposición:
68 pacientes(49%) egresaron desde guardia. 43 pacientes(32%) Ingresaron a
UCO/UTI. 27 pacientes(19%) Ingresaron a sala general. Mortalidad: 1.4%(2 pacientes).
Anticoagulación en altas de guardia: 9%. CHA2DS2-VASc
promedio altas guardia: 2.
Discusión y Conclusiones: Se describen las características de la
población que consulta con FA al DE un Hospital Privado de la Provincia de
Buenos Aires. Existe una alta proporción de detección de FA en guardia. La
mayoría de los pacientes tuvo síntomas leves/moderados. La mortalidad
hospitalaria es comparable con otras series. En el período analizado se
registraron en total 141915 consultas clínicas, los 138 casos incluidos
representan aproximadamente el 0.1% de las consultas; entendemos que existe un
subregistro de la patología. La creciente accesibilidad a los Anticoagulantes
Orales Directos (DOAC) ayudará a aumentar, en los casos que está indicado, la
baja tasa de anticoagulación al alta de guardia observada. Se requiere
protocolización para facilitar la toma de decisiones en la urgencia (control de
ritmo, cardioversión, anticoagulación, etc.) optimizando el flujo de pacientes,
brindando resolución rápida y segura y disminuyendo los costos.
Referencias: NEJM.2019
Apr18;380(16):1578-1579.doi:10.1056/NEJMe1902341.
WJEM.2013 Feb;14(1):55-7.
doi:10.5811/westjem.2012.1.6893.
KM Manzur(1), KM
Manzur, ADLM Manzur(2)
(1) -. (2) Sanatorio Mayo.
Introducción: La muerte es un proceso biológico,
psicológico y social. Este estudio analizó la relación entre las actitudes ante
la muerte y las creencias sobre el paciente terminal en una muestra de
enfermeros y posteriormente las comparó según el tipo de servicio en el que se
desempañaron durante la pandemia Covid-19 en el año 2020.
Metodología: Estudio transversal, correlacional y
comparativo. La unidad de análisis fueron enfermeros que trabajaban en terapia
intensiva y clínica médica. El instrumento que mide actitudes ante la muerte
está formado por 33 reactivos y las clasifica en evitación, aceptación, temor,
pasaje/tránsito, salida/solución y perspectiva profesional, el grado de acuerdo
se expresa de 1 a 5. El instrumento que mide creencias sobre el paciente
terminal está conformado por 15 ítems, el grado de acuerdo se expresa de 1 a 7.
Los datos fueron analizados con el software SPSS.
Resultados: La muestra estuvo integrada por 78
enfermeros, el 57.7% de Terapia Intensiva y el 42.3% de Clínica Médica. No se
expresaron actitudes polarizadas ante la muerte (Tabla 1), sin embargo, la que
obtuvo mayor puntaje fue aceptación. Se encontró una correlación positiva y
estadísticamente significativa entre la actitud de aceptación y las creencias
de que tanto para el familiar y para el enfermo lo mejor es que muera en su
casa (p=0.001) y la importancia de que reciba apoyo psicológico y espiritual
(p=0.003) (Tabla 2). A pesar de que la creencia con mayor desacuerdo (Media
2.23; DS1.78; Me 1) corresponde a que enfermería puede intervenir muy poco en
el proceso de morir de un enfermo terminal, obtuvo una correlación positiva y
estadísticamente significativa con la actitud de temor ante la muerte. En el
análisis comparativo por servicio, los enfermeros de UTI expresaron mayor
acuerdo (Media 5.36) que los de clínica médica (Media 4.42) sobre la creencia
de que tanto para el familiar como para el enfermo, lo mejor es que muera en su
casa (p=0.034). No se encontraron diferencias significativas entre las
actitudes ante la muerte y el tipo de servicio.
Conclusiones: Las actitudes ante la muerte y las creencias
sobre el paciente terminal están relacionadas.


KM Manzur(1), MS
Menghi(1)
(1) Universidad Católica Argentina - Facultad
Teresa De ávila.
Introducción: Los padres de niños con parálisis cerebral se
enfrentan a las alteraciones motoras, sensoriales, cognitivas y emocionales de
sus hijos. La sobrecarga es el conjunto de problemas físicos, psicológicos o
emocionales, sociales y económicos que pueden ser experimentados por una
persona que realiza tareas de cuidado. El objetivo de este estudio fue
investigar la relación entre la sobrecarga del cuidador y el tipo de
alimentación y función motora del paciente.
Metodología: Estudio cuantitativo, transversal,
comparativo. La unidad de análisis fueron cuidadores primarios de pacientes con
parálisis cerebral infantil. El instrumento que mide Sobrecarga en el Cuidador
está formado por 22 ítems y 5 dimensiones: sobrecarga en la relación, bienestar
emocional, vida social y familiar, finanzas, pérdida de control sobre la vida
de cada uno. El grado de acuerdo se expresa de 0 a 4. La sobrecarga total se
obtiene sumando los puntajes y las categorías son: sin sobrecarga (≤46),
sobrecarga leve (47-55), sobrecarga intensa (≥56). El tipo de alimentación se
categorizó en: boca, sonda nasogástrica, botón gástrico y combinado. La función
motora gruesa se clasifica en niveles de 1 a 5, a mayor nivel aumentan las
limitaciones. Los datos fueron analizados con el software SPSS.
Resultados: La muestra estuvo integrada por 90
cuidadores, el 98,9% de género femenino y en el 92,2% de los casos el rol era
cumplido por la madre. El 85,55% no presentó sobrecarga, el 5.55% tuvo una
sobrecarga leve y el 8.89% intensa. Las dimensiones con mayor puntaje fueron
finanzas, sobrecarga en la relación y pérdida de control sobre la vida de cada
uno. El tipo de alimentación por boca (Figura 1) y el nivel 5 de la función
motora gruesa (Figura 2) fueron predominantes. Por último, la sobrecarga del
cuidador fue independiente del tipo de alimentación y función motora del
paciente.
Conclusiones: La sobrecarga como constructo
multidimensional expresa necesidades que deben ser atendidas porque el cuidador
es el receptor de las indicaciones terapéuticas de cada disciplina que aborda
al paciente pediátrico.


C Videla(1), P
Plou(1), L Valencia Chicue(1), C Yampolsky(1), P Ajler(1), N Ciarrocchi(1)
(1) Hospital Italiano De Buenos Aires.
Introducción: La hemorragia intracerebral (HIC) es el
segundo subtipo más común de accidente cerebrovascular y está asociada con
tasas elevadas de discapacidad o mortalidad, siendo uno de los factores de mal
pronóstico el volumen del hematoma. El ensayo Mistie III, con objetivo de
disminuir el tamaño del hematoma, demostró que a mayor reducción de la HIC,
menor mortalidad, sin un aumento neto en la proporción de pacientes con discapacidad
grave. En este trabajo se describe la experiencia de cuatro años de un hospital
universitario de Argentina con el tratamiento de pacientes seleccionados con
HIC según el protocolo Mistie.
Métodos: Se realizó un análisis retrospectivo de casos
consecutivos con HIC tratados con el protocolo Mistie en un solo centro
universitario de tercer nivel de atención desde 2017 hasta 2021.
Resultados: Se implementó
este procedimiento en 7 pacientes con HIC con una mediana de edad de 61 años,
una mediana de NIHSS de 14, un volumen de 35 ml y una mediana de puntuación de
ICH score de 2. Cinco de 7 pacientes lograron el objetivo de reducción del
hematoma, cuatro de los pacientes tenían un nivel de independencia total y uno
necesitaba ayuda mínima a los 12 meses del alta. Cinco pacientes tuvieron un
buen resultado funcional (mRS 0-3 y eGOS 4-8) y dos pacientes fallecieron pero
ninguno a causa de las consecuencias de la trombolisis de la hemorragia
intracerebral. No se presentaron complicaciones hemorrágicas durante la
colocación del catéter, infusión de alteplasa o posterior al retiro del
catéter.
Conclusión: El tratamiento quirúrgico con craneotomía y
evacuación del hematoma en pacientes con HIC sigue siendo motivo de debate. La
técnica mínimamente invasiva puede ser útil para reducir la mortalidad y
mejorar los resultados neurológicos en pacientes seleccionados. Se presentan
los primeros datos obtenidos de una cohorte en Sudamérica con resultados
similares a los obtenidos en el ensayo MISTIE y en cohortes posteriores,
brindando al procedimiento de validación en nuestro medio.

U Zaya(1), A
Aliscioni(1), Y Saldivar(1), R Alvarez(1), F Irades(1), N Kessler(1), P
Tejerina(1), C Firme(1), P Calcagno(1), E Minoldo(1), C Galletti(1)
(1) Sanatorio Allende.
Introducción: Se describió un síndrome protrombótico en
personas vacunadas con AstraZeneca, denominado trombocitopenia trombótica
inmunitaria inducida por vacunas -TTIV- (VITT por sus siglas en inglés). Se
expone la presentación clínica, evolución y los estudios que lo ilustran,
contrastándolo con la bibliografía disponible.
Caso Clínico: Paciente masculino de 34 años, sano previo.
Tuvo COVID-19 en julio de 2021. Se aplicó tercera dosis de vacuna con
AstraZeneca el 14 de marzo de 2022. El 18 de abril consulta por epigastralgia
de 7 días de evolución asociado a vómitos alimenticios y diarrea y signos
clínicos de irritación peritoneal. Se interna en UCI. Se realizó tomografía de
abdomen: trombosis venosa de porta, mesentérica superior, y esplénica, edema de
asas yeyunales e infarto esplénico. En laboratorio trombocitopenia y Dímero D
elevado. Evoluciona con empeoramiento clínico, letargo y foco motor, se presume
trombosis cerebral. Angio RMN de cerebro: focos de hemorragia
corticosubcortical frontal bilateral y trombosis del seno longitudinal superior
y de venas corticales en la convexidad frontoparietal bilateral. Se sospecha TTIV.
Se inicia anticoagulación con enoxaparina e inmunoglobulina (IG). Se solicita
anticuerpo anti factor plaquetario 4 (AcPF4). Se descartan otras patologías.
Evoluciona con FMO y coagulación intravascular con hemorragia digestiva. 36
horas luego, midriasis bilateral con reflejos de tronco abolidos, TC de
cerebro: extensa área de hemorragia en lóbulo frontal derecho y ventrículo
lateral, desplazamiento la línea media y hernia central con compresión
mecensefálica. Signos de muerte encefálica clínicos y en doppler transcraneal.
Discusión y conclusiones: La TTIV es inusual. Se desconoce la
incidencia exacta. Los Ac PF4 sobreestimulan el sistema de coagulación y causan
complicaciones tromboembólicas significativas en sitios venosos típicos, no
obstante, una característica distintiva es la trombosis en sitios inusuales. La
ventana es variable después de la vacunación, entre 5 a 30 días después. La TVC
parece ser el sitio más común. El Ac PF4 positivo es confirmatoria. La
anticoagulación es mandatoria. Se asocia altas dosis de IG para contrarrestar
la activación plaquetaria inducida por anticuerpos. El pronóstico es difícil de
establecer. Los factores de riesgo de muerte incluyen TVC y anomalías
hemostáticas pronunciadas tal como ocurrió en el caso que se presenta.


0018 ÁCIDO TRANEXÁMICO EN
TRAUMATISMO DE CRÁNEO LEVE Y MODERADO CON LESIÓN TOMOGRÁFICA
ME Blessio(1), PB
Pahnke(1), I Puig(2)
(1) Hospital Municipal De Urgencias. (2)
Ospital Municipal De Urgencias.
Introducción: El traumatismo de cráneo (TEC) encabeza la
lista de discapacidad neurológica en adultos jóvenes, y es considerado un
problema prevalente en Salud Publica, incrementando los costos y
morbi-mortalidad del sistema. Para tratar esta problemática la utilización de
Ácido Tranexámico (ATX) en los últimos años ha adquirido importancia radical,
comprobándose a través de grandes estudios que reduce considerablemente la
mortalidad en pacientes con traumatismo de cráneo leve-moderado.
Metodología: Estudio de cohortes ambispectivo. En la fase
prospectiva se incluyeron pacientes que tenían entre 15-80 años, que se
encontraban dentro de las primeras 3 hs posterior al trauma y que además tenían
un TEC leve o moderado por Escala de coma de Glasgow (GCS) y lesión tomográfica
de tipo hemorrágica a nivel cerebral. A este grupo se les administró ATX. En la
fase retrospectiva se analizaron datos de una cohorte similar al grupo
anterior, pero que no recibieron ATX. Se evaluó el comportamiento de las
lesiones hemorrágicas a través del análisis de imágenes tomográficas seriadas,
su relación con el volumen del hematoma inicial y con la mortalidad asociada.
Resultados: El incremento de volumen total hemorrágico en
el grupo de los que no se les administro ATX, fue estadísticamente
significativo (p=0,05) (Gráfico 1) principalmente en aquellos que tenían un
volumen hemorrágico inicial de entre 10 – 24,99 cc (Gráfico 2). En cuanto al
análisis de lesiones hemorrágicas por separado, ocurrió mayor aumento de
lesiones hemorrágicas significativas (>25%) y aparición de nuevas lesiones
cerebrales focales en el grupo de los que no estuvieron expuestos al fármaco.
Además se encontró un leve beneficio asociado a la utilización de ATX en TEC
leves que en los moderados.
Conclusiones: Este ensayo demuestra el papel fundamental que
cumple el ATX en el TEC, al disminuir la probabilidad de aumento de las
lesiones hemorrágicas dentro de las primeras horas desde el traumatismo,
principalmente en aquellos con volumen lesional inicial de entre 10 a 25 cc.
Pudiendo ser el tamaño del hematoma un parámetro más certero que el puntaje en
la GCS a la hora de indicar la administración del fármaco.


AD Bujedo(1), MC Vignetta(1),
PB Pahnke(1)
(1) Hospital Municipal De Urgencias.
En pacientes con traumatismo pélvico cerrado,
la hemorragia es la principal causa de muerte prematura. La angioembolización
(AE) es el método de elección para esta patología. Los trastornos de
coagulación asociados al trauma son una entidad frecuente y ampliamente
estudiada. En el Hospital Municipal de Urgencias se aplica un protocolo de
atención en pacientes con sangrado activo y coagulopatía inducida por trauma
(SATIC) desde el año 2015. El acceso a la AE no siempre se encuentra
disponible; es por ello que se plantea el interrogante de si ésta es una
herramienta indispensable para el tratamiento.
Se estudiaron 39 pacientes, la mayoría masculinos, de 37.6 años en
promedio. El motivo de ingreso más frecuente fue el de colisiones vehiculares y
el mecanismo lesional por compresión antero-posterior, en su mayoría WSES grado
IV. Según la clasificación de Tile, predominaron las fracturas tipo B. Cinco
fueron AE, a pesar de que más de la mitad de la muestra cumplía con los
criterios establecidos para su realización. El tiempo puerta-balón, fue mayor
al recomendado. Al ingreso, la mayoría presentó un Grado de Hemorragia II
(según valor de lactato). A pesar de que la reanimación con hemoderivados se
realizó en gran parte por fuera de los parámetros protocolares establecidos, la
evolución hemodinámica fue favorable. El tiempo promedio de internación fue de
18.4 días, y fue aún mayor en los pacientes embolizados. Del total de
pacientes, solo 2 fallecieron.
En la actualidad, existe una amplia gama de tratamientos para este
tipo de patología. En nuestra experiencia, hemos detectado falta de unificación
en los criterios a la hora de abordar a estos pacientes.
0020 Injuria por inhalación:
serie de casos sobre manejo broncoscópico
J González Anaya(1),
I Carboni Bisso(1), V Ruiz(1), F Rosciani(1), I Fernández Ceballos(1), M Las
Heras(1)
(1) Hospital Italiano De Buenos Aires.
Introducción: La injuria pulmonar por inhalación constituye
una entidad aumenta la mortalidad de las víctimas de incendios. Puede afectar a
la vía aérea tanto a nivel supra como infraglótico, con compromiso sistémico
mediado por la respuesta inflamatoria secundaria a la injuria local y a la
toxicidad de los componentes de combustión.
Presentamos una serie de casos que reflejan
la experiencia de nuestra institución en el manejo broncoscópico y tratamiento
de estos pacientes.
Serie de casos: Reportamos los resultados de 8 pacientes que
cursaron internación en unidad de cuidados intensivos (UCI) de un centro de
alta complejidad de la Ciudad de Buenos Aires entre enero de 2018 y julio de
2022.
6 de los 8 pacientes fueron de sexo femenino,
con una mediana de edad de 52 años (rango interquartilo [RIC] 35-74), y una
mediana de score APACHE II 9 (RIC 6-15).
Todos los pacientes fueron evaluados por
broncoscopia para visualización de la vía aérea (VA) y toilette bronquial. Un
paciente presentó lesión supraglótica de la VA, 2/8 lesión infraglótica, 4/8
tanto infraglótica como supraglótica, y un paciente no presentó lesiones de la
VA (la figura 1 ilustra las diferentes lesiones de la VA). Todos los pacientes
recibieron n-acetilcisteína nebulizada y 6/8 heparina sódica nebulizada. 7
pacientes requirieron ventilación mecánica invasiva y 5 traqueostomía como
método de weaning. La mediana de días de UCI fue 30 (RIC 10-48). La mortalidad
de la serie fue 0/8 aunque dos pacientes continúan internadas a la fecha. La
tabla 1 ilustra las características clínicas y los resultados de los pacientes.
Discusión: La detección precoz de la injuria por
inhalación y su compromiso infraglótico es de suma importancia para instaurar
medidas específicas como la broncoscopia seriada para remoción de los restos
carbonáceos, así como también para la iniciar medidas como acetilcisteína y
heparina nebulizada. Asimismo, el conocimiento de la fisiopatología de la
intoxicación por cianuro y monóxido de carbono, y otros compuestos
alquitranados, permiten tomar medidas en la reanimación inicial con el objetivo
de prevenir lesiones en órganos blanco (generalmente corazón y cerebro).


C Hajdinjak(1), A
Fernandez(1), A Avila(1), S Palletti(1)
(1) Durand.
Introducción: Las complicaciones autoinmunes
postinfecciosas puede asociarse a infeccion por mycoplasma. Hasta un 25% de ls
complicaciones son extrapulmonares, siendo los trastornos neurológicos los más
frecuentes. Las manifestaciones cardíacas son raras. No existen reportes de
presentacion simultanea de estas complicaciones.
Presentacion de caso: Paciente de 8 años previamente sano ingresa a
UCI con distress respiratorio agudo, virus sincitial respiratorio positivo,
para ventilación mecánica (AVM). Durante el plan de destete, presenta
miocarditis aguda e hipertensión pulmonar (HP), tratadas con vasopresores,
sildenafil y gammaglobulina (día +14). Se tomaron cultivos (negativos) y se
amplió la búsqueda a mycoplasma (IgM positivo) y otros virus (negativo). El
ecocardiograma evidenció inicialmente HP moderada, que se normalizó en el día
+21. Se realizó traqueostomía luego de dos extubaciones fallidas, en los días
26 y 32, debido a polineuropatía, con progresion bulbar. En este contexto, se
consideraron diagnósticos adicionales. El electromiograma confirmó Guillain
Barré, a pesar de que la punción lumbar no mostró disociación albúmina
citológica. Se administró gammaglobulina intravenosa. El día +55, presentó
encefalopatía aguda y signos de extrapiramidalismo, inicialmente sospechado
como hipóxico-isquémico. La resonancia magnética fue normal y el
electroencefalograma mostró onda Delta Brush. Asumiendo encefalitis
inmunomediada (posteriormente confirmada con anticuerpos NMDA positivos en
plasma), se trató con pulso de metilprednisolona. Día +70 se desvinculó de AVM.
Se dio de alta recuperado
Discusión: La secuencia de miocarditis, polineuropatia y
encefalitis autoimnune secundaria a mycoplasma no ha sido no reportada .Las
manifestaciones extrapulmonares mas frecuentes son los desórdenes neurologicos:
encefalitis y meningoencefalitis principalmente, tambien meningitis aseptica,
Sindrome Guillain Barre (SGB), sindrome cerebeloso, mielitis transversa,
epilepsia, sintomas psiquiatricos y neuritis optica. La asociacion de SGB y
Encefalitis no es frecuente y la segunda suele preceder a las manifestaciones
perifericas. Las manifestaciones cardiacas son raras (1-8.5%) y en UTIP es mas
frecuente el compromiso secundario a sepsis y a infecciones virales.
Conclusión: Debido a la frecuencia y al cuadro clínico,
la primera sospecha diagnóstica fue la polineuropatía del paciente crítico y la
encefalopatía hipóxica isquémica. Sin embargo, este caso clínico nos muestra la
importancia de considerar otras patologías menos frecuentes que, tratadas
adecuadamente, permitan una recuperación completa.


J González Anaya(1),
I Carboni Bisso(1), V Ruiz(1), M Baglioni(1), E Villanueva(1), I Huespe(1), S
Di Stefano(1), M Las Heras(1), M Falconi(1), J Sinner(1)
(1) Hospital Italiano De Buenos Aires.
Introducción: El tránsito de burbujas transpulmonares
(TBTP) detectado con ecocardiografía de contraste se reporta como un signo de
shunt arteriovenoso intrapulmonar (Figura 1). Sin embargo, su significado
patológico en el síndrome de distrés respiratorio agudo (SDRA) relacionado con
la enfermedad por coronavirus-2019 (COVID-19) no está claro. Nuestro objetivo
fue determinar la prevalencia y la significancia clínica de la detección de
TBTP durante el SDRA relacionado con COVID-19.
Métodos: Realizamos un estudio observacional
prospectivo, en una unidad de cuidados intensivos de alta complejidad de Buenos
Aires, durante la primera ola de la pandemia en Argentina. Los pacientes con
SDRA relacionado con COVID-19 se sometieron a una ecocardiografía transtorácica
con contraste salino. El TBTP moderado a severo se definió como el paso de
derecha a izquierda de al menos doce burbujas a las cavidades izquierdas,
después de al menos tres ciclos cardíacos, con opacificación completa de la
aurícula derecha (ver Figura 2).
Resultados: Se analizaron los resultados de 28 pacientes
(24 hombres y 4 mujeres). El setenta y cinco por ciento de los pacientes
recibieron ventilación mecánica invasiva. Se detectó TBTP de moderado a severo
en 1 paciente (3,5%). Entre los 27 pacientes sin TBTP significativo, 23 no
tenían TBTP y 4 tenían un TBTP leve. El TBTP no se asoció con la necesidad de
ventilación mecánica invasiva (p = 0,5737) ni con la mortalidad hospitalaria (p
= 1).
Conclusiones: El TBTP no se asoció con hipoxemia grave o
necesidad de ventilación mecánica invasiva, aunque se necesitan más estudios
para aclarar si tiene un papel contribuyente en la hipoxemia por COVID-19.


FC Rosciani(1), VA
Ruiz(1), I Carboni Bisso(1), S Di Stefano(1), SE Giannasi(1), FG Wright(1), MA
Sian(1), FL Negri Rico(1), C Juana(1), G Galli(1), MJ Las Heras(1), I Fernández
Ceballos(1)
(1) Hospital Italiano De Buenos Aires.
Objetivo: Evaluar la evolución clínica en pacientes sometidos
a esofagectomía según la reserva funcional (RF) preoperatoria.
Métodos: Estudio observacional de cohorte
retrospectivo de pacientes sometidos a esofagectomía. Se estimó el riesgo
postoperatorio según test cardiopulmonar (TCP) y comorbilidades.
Resultados: Desde el 2011 al 2022 se incluyeron 174
pacientes, 135 (78%) de sexo masculino, mediana de edad 62 años. Charlson,
Apache II y SOFA fueron 5, 7 y 1 respectivamente.
Las comorbilidades más frecuentes fueron:
enfermedad oncológica (98%), HTA (45%), tabaquismo (41%) e insuficiencia
cardiaca (18%). Al ingreso el 60% presentó desnutrición. Solo el 15% recibió
soporte nutricional preoperatorio. El 71% realizó quimioterapia y el 54%
radioterapia.
32% fueron categorizados de alto riesgo (AR).
El origen del deterioro de la RF fue: desacondicionamiento (44,5%), cardíaco
(40,7%) y respiratorio (14,8%).
El 30% de los pacientes con estudios
funcionales respiratorios (EFR) alterados presentaron una RF normal. El 44% con
EFR normales tuvieron un RF alterada.
La tasa global de complicaciones fue 44,3%,
siendo graves (requerimiento de AVM) el 13,8%. La mortalidad global fue 4%.
El 37% de los que requirieron AVM fueron de
AR, con mortalidad de 40%, vs 21% en pacientes de bajo riesgo.
Discusión: El TCP valora la RF mediante la estimación de
la tolerancia al estrés postoperatorio, y su alteración pone en evidencia el
riesgo de no tolerar complicaciones graves, y por ende mala evolución clínica.
Este estudio demostró alta prevalencia de
desnutrición, bajo soporte nutricional preoperatorio y mayor mortalidad en
pacientes de AR en AVM.
El TCP detectó pacientes de AR con EFR
normales, y pacientes con RF conservada y EFR alterados.
Tanto la desnutrición como la RF alterada son
factores modificables preoperatorio, por lo que su detección preoperatoria y su
tratamiento podría mejorar la evolución clínica.
Conclusión: La valoración de la RF y el estado
nutricional preoperatorio brinda información sobre la tolerancia a
complicaciones postoperatorias graves de la esofagectomía, por lo que su
detección permite implementar un plan nutricional y de rehabilitación
preoperatoria con el objetivo de minimizar los riesgos postoperatorios y así
mejorar la evolución posoperatoria.
0025 MONITOREO REMOTO DE LA
GLUCEMIA DURANTE LA PANDEMIA SARS-CoV-2: SERIE DE CASOS
L Bujan Molins(1), I
Carboni Bisso(1), F Garelli(2), H De Battista(2), R Sánchez-peña(3), E San
Román(1), L Grosembacher(1), M Las Heras(1)
(1) Hospital Italiano De Buenos Aires. (2)
Universidad Nacional De La Plata. (3) Instituto Tecnológico De Buenos Aires.
Introducción: Dentro de las complicaciones generadas por la
enfermedad por coronavirus 2019 “COVID-19”, el manejo de la glucemia suscitó un
problema severo. A continuación presentamos una serie de casos en los que se aplicó
nuevos sistemas de monitoreo de glucemia remoto con el objetivo de reducir la
exposición del personal de salud. La monitorización consiste en una conexión
inalámbrica con sensores subcutáneos de glucosa y bombas de insulina que
permite acceder a información simultánea e instantánea desde computadoras o
teléfonos celulares.
Métodos: Estudio prospectivo, observacional, realizado
en unidad de cuidados intensivos (UCI) de la Ciudad Autónoma de Buenos Aires
durante la primera ola de la pandemia en Argentina. Se realizó monitoreo de
glucemia continuo (MGC) utilizando el dispositivo DexcomG6 y la plataforma de
monitorización InsuMate, disponible online (www.insumate.com.ar). En cuanto al
protocolo de insulinoterapia objetivo los niveles de glucemia propuestos fueron
de 140-180mg/dl, con una infusión continua de insulina cercana a 0,7-1.4UI/kg.
Resultados: Los resultados de 3 pacientes con COVID-19
severo en UCI con MGC fueron evaluados. La figura 1 demuestra la interfaz de la
plataforma y los resultados principales de la monitorización donde puede
observarse de manera detallada los últimos 8 días la evolución y controles de
glucemia.
Discusión y conclusión: En contexto de paciente crítico COVID (con
requerimiento de ventilación invasiva, uso de glucocorticoides y diversas
comorbilidades como trasplantados renales, obesidad, hipertensión, etc) se ha
requerido valores de insulina mucho mayores a los propuestos en consecuencia de
un manejo desafiante de glucemia para el logro de los objetivos establecidos.
Sin embargo no debe pasar desapercibido 2
resultados de relevancia ante la implementación de este método. Por un lado es
interesante el casi nulo registro de eventos de hipoglucemia en contraposición
con los normalmente esperables en el tratamiento basado en mediciones de
glucemia convencionales. Por otro lado, se logró un porcentaje cercano al 50%
de valores de glucosa normales (Figura 2).
Estos beneficios sumados a la menor
exposición del personal de salud son de relevancia para la mejora del control
de glucemia y seguridad de los los integrante de la UCI.


I Carboni Bisso(1),
D ávila Poletti(1), A Massó(1), E Prado(1), JM Nuñez Silveira(1), E Sosa(1), P
Buchanan(1), R Aimé(1), V Richter(1), M Buscaglia(1), MR Risk(1), J Sinner(1),
M Las Heras(1), I Huespe(1)
(1) Hospital Italiano De Buenos Aires.
Introducción: El síndrome de distrés respiratorio agudo
(SDRA) relacionado a COVID-19 aumentó drásticamente el número de pacientes que
requirieron ventilación en decúbito prono (VDP). Cada ciclo completo de VDP
insume al menos 17 horas en prono y requiere aproximadamente una hora de
trabajo, con un mínimo de tres operadores para posicionar al paciente. Durante
el desarrollo de la pandemia, Douglas y colaboradores propusieron una
estrategia de VDP protocolizada en las que el reposicionamiento a supino sólo
se efectivizaba cuando se alcanzaban parámetros específicos de oxigenación. El
objetivo de este estudio fue evaluar si la VDP protocolizada en pacientes
críticos ventilados por SDRA COVID-19, reduce el número de ciclos de pronación
/ supinación.
Métodos: Realizamos un estudio prospectivo
cuasi-experimental de antes y después. Entre el 1 de octubre de 2020 y el 30 de
abril de 2021, se incluyeron pacientes hospitalizados en la unidad de cuidados
intensivos (UCI) de un hospital universitario de alta complejidad de Buenos
Aires, que estuvieron expuestos a la VDP estándar. El grupo de comparación
estuvo formado por pacientes hospitalizados entre el 1 de mayo de 2021 y el 1
de octubre de 2021 que fueron tratados con la estrategia de VDP protocolizada.
Resultados: Se incluyeron 64 pacientes con la estrategia
VDP estándar y 16 pacientes con VDP protocolizada. No se encontraron
diferencias significativas entre el grupo de VDP estándar vs VDP protocolizada
(pacientes con más de un ciclo: 42,2% [n=27] vs. 62,5% [n=10]; p=0,18). Además,
no se encontraron diferencias estadísticas en los días libres de ventilación
mecánica a los 90 días, estadía en UCI, estadía hospitalaria, ni en la
mortalidad hospitalaria.
En cuanto a las úlceras por presión (UPP), la
estrategia de VDP protocolizada se asoció con un aumento en el desarrollo de
lesiones torácicas y abdominales. Respecto a las complicaciones asociadas a la
maniobra de pronación/supinación, ambas estrategias presentaron resultados de
seguridad similares.
Conclusión: La VDP protocolizada frente a la estrategia
estándar de VDP para el SDRA grave por COVID-19 no dio como resultado una
reducción en los ciclos totales de VDP, pero aumentó la frecuencia de UPP
asociadas a la VDP.
W Dávalos(1), S
Torres(1), A Rivera(1), N Vergottini(1), A Massó(1), R Quiroga(1)
(1) Sanatorio Anchorena San Martín.
Introducción: La ergotamina es un fármaco antimigrañoso,
puede presentar efectos adversos debido a sus propiedades vasoconstrictoras.
Reportamos el caso de una paciente con accidente cerebrovascular isquémico y
síndrome coronario agudo por intoxicación con ergotamina, con múltiples áreas
de isquemia cerebral con transformación hemorrágica y secuelas que motivaron su
derivación a un centro de rehabilitación.
Presentación del caso: Paciente de 41 años de sexo femenino con
antecedentes de cefalea crónica, asma, tabaquismo y uso de descongestivo nasal.
Consulta por cuatro días de evolución de deterioro del sensorio y déficit motor
focal derecho. Presentó incremento en el uso de ergotamina en la última semana
(3 a 4 comprimidos por día).
Del examen físico se destacan el sensorio
alternante y plejía braquiocrural derecha y del laboratorio troponina de alta
sensibilidad de 9104 pg/ml. Con tomografía y resonancia de cerebro con áreas de
isquemia corticosubcorticales con transformación hemorrágica.
Ecocardiograma Bidimensional con hipokinesia
anterolateral medio y apical. Fey de 41%, sin elevación del ST en el
electrocardiograma.
En la cine coronariografía se informó
descendente anterior con déficit de relleno a nivel apical.
Fue tratada con apirina 100 mg/día,
atorvastatina 80 mg/día
y suspensión de ergotamina
Fue derivada a un centro de rehabilitación. A
su egreso la paciente se encontraba vigil, obedeciendo órdenes, bradipsíquica,
con hemiparesia derecha moderada a predominio braquial.
Discusión: La acción vasoconstrictora de la ergotamina
se debe que actúa a nivel de los receptores de aminas biogénicas.
La presentación de dos efectos adversos
graves en el mismo paciente es muy infrecuente y se encuentran pocos reportes
de casos que los describan.
Conclusión: Si bien los triptanos son más eficaces y
seguros para el tratamiento de la migraña se sigue empleando ergotamina debido
al fácil acceso a la misma, pudiendo obtenerse en algunas farmacias sin receta,
lo que facilita la aparición de efectos adversos graves.

CE Maenza(1), NS
Rocchetti(1), M Ramírez Colombres(1), M Latimori(1), FR Dipaolo(1), F
Garavelli(1), SP Gattino(1), MD Ré(1), CJ Settecase(1), DH Bagilet(1)
(1) Hospital Escuela Eva Perón.
Introducción: El virus SARS-Cov-2, perteneciente a la
familia Coronaviridae y causante de la pandemia por COVID-19 (Coronavirus
Disease), generó una crisis sanitaria sin precedentes.
Objetivo: Describir características clínicas,
analíticas y evolutivas de una cohorte de pacientes críticos con enfermedad por
COVID-19 ingresados en una Unidad de Cuidados Intensivos (UCI) durante el año
2021 en Argentina.
Métodos: Estudio observacional, descriptivo,
retrospectivo y de corte transversal. Realizado en una UCI polivalente,
incluyendo ≥18 años, con diagnóstico de SARS-CoV-2 y enfermedad grave por
COVID-19, durante un período de 12 meses (01/01/2021 - 31/12/2021). Variables:
demográficas, comorbilidades, escalas de gravedad, requerimiento de ventilación
mecánica (VM), analíticas, shock, SDRA y adyuvantes, fracaso renal, estancia en
UCI y en VM, y resultado.
Resultados: 314 pacientes con COVID-19 grave y
requerimiento de UCI. Mediana de edad: 53 años (RI 40-60); 56,2% eran varones,
38,4% presentó HTA, 32,7%% DBT y 33,7% obesidad. 32 pacientes vacunados contra
SARS-CoV-2. Mortalidad: 67,9%. Aquellos con evolución desfavorable presentaron
mayor APACHE II (Acute Physiology and Chronic Health Evaluation), SOFA
(Sequential Organ Failure Assessment), requerimiento de VM, SDRA grave,
decúbito prono, presencia de shock, insuficiencia renal aguda (IRA) con
vinculación a hemodiálisis, días de estancia en UCI y VM, mortalidad y aumento
de biomarcadores (lactato deshidrogenasa, leucocitosis, Proteína C reactiva,
interleucina 6 (IL-6), procalcitonina, ácido láctico, troponina T, pro péptido
natriurético B), fracción inspirada de oxígeno (FIO2) y el índice PaO2/FiO2 al
ingreso y al alta de la UCI (Tabla 1). A través del análisis de regresión
logística multivariante se identificó al APACHE (OR 1,070; IC 95% 1,008–
1,136), requerimiento de VM (OR 4,916; IC 95% 1,801 – 13,419), presencia de
shock (OR 2,084; IC 95% 1,056 – 4,113), SDRA (OR 2,563; IC 95% 1,154- 5,694),
IRA (OR 4,540; IC 95% 2,069- 9,964) e IL-6 > 18,45 pg/ml (categórica) (OR
3,308; IC 95% 1,614 -6,783) como predictores independientes de mortalidad.
Conclusiones: Variables como APACHE, VM, shock, SDRA, IRA o
IL > 18,45 pg/ml fueron predictores independientes de mortalidad en una
población de adultos críticos con COVID-19 de la Argentina. Estos datos
tendrían valor para mejorar el manejo en UCI de pacientes graves con esta
enfermedad.
CE Maenza(1), NS
Rocchetti(1), M Ramírez Colombres(1), M Latimori(1), FR Dipaolo(1), F
Garavelli(1), SP Gattino(1), MD Ré(1), CJ Settecase(1), DH Bagilet(1)
(1) Hospital Escuela Eva Perón.
Objetivo: Estudiar la capacidad predictiva de los
biomarcadores séricos IL-6, PCR y PCT, medidos al momento del ingreso a UCI,
sobre la mortalidad en la misma, en pacientes críticos con COVID-19.
Diseño: Estudio analítico, observacional, de
corte transversa y retrospectivo.
Ámbito: Unidad de Cuidados Intensivos
polivalente.
Pacientes: ≥18 años, con diagnóstico de
SARS-CoV-2 y enfermedad grave por COVID-19.
Intervenciones: Ninguna.
Variables de interés: Edad, sexo, APACHE II
(Acute Physiology and Cronic Health Evaluation), SOFA (Sequential Organ Failure
Assessment), comorbilidades, necesidad de oxigenoterapia a través ventilación
mecánica (VM) y días de esta última. IL-6 (pg/ml), PCR (mg/dl) y PCT (ng/ml).
Fracción inspirada de oxígeno (FIO2) y el índice PaFiO2 (PaO2/FiO2) al ingreso
y al alta de la UCI, presencia de shock, tipo de SDRA, requerimiento de decúbito
prono, falla renal aguda y requerimiento de hemodiálisis, resultado en UCI
(favorable o muerte) y días de internación en la misma.
Resultados: Se incluyeron 314 pacientes; mediana de edad
53 años (40-60); varones 56,2%; necesidad de oxígeno a través de VM 86,3% y
mortalidad 67,9%. La IL-6, PCR y PCT fueron más elevadas en el grupo de
evolución desfavorable 16,70; RI 8,05 – 45,55 versus 51,20; RI 109,40 – 20,50,
p= <0,001; 8,55; RI 3,9 – 13,55 versus 11,95; RI 5,1 – 19,80, p= 0,012 y
0,13; RI 0,08 – 0,35 versus 0,24; RI 0,24 RI 0,10 – 0,75, p= 0,001
respectivamente). El valor del AUC obtenido para la IL-6 fue de 0,691 (IC 95:
0,629 – 0,754, p= <0,001), mientras que para la PCR fue de 0,588 (IC 95:
0,523 – 0,653, p= 0,012) y en el caso de la PCT de 0,612 (IC 95: 0,547 – 0,677,
p= 0,001).Al análisis multivariado, la IL-6 >18,45 pg/ml, requerimiento de
VM y presencia de shock se mantuvieron como factores de riesgo independiente de
mortalidad.
Conclusiones: La determinación de IL-6 presento una mayor significancia
estadística, en relación a PCR y PCT, para evaluar la capacidad predictiva de
mortalidad en pacientes críticos con COVID-19.
0030 Abdomen agudo de etiología
poco frecuente en el puerperio
M Montenegro(1), P
Okurzaty(1), MA Balauz(1), S Galceran(1)
(1) Hospital Mi Ramón Sardá.
Introducción: El abdomen agudo en la paciente obstétrica
representa un desafío que a menudo implica retraso diagnóstico y terapéutico
resultando en una mayor morbimortalidad.
Presentación: Paciente de 36 años cursando embarazo de
término ingresa por Ruptura Prematura de Membranas de 1,5 horas de evolución.
Se realiza parto forcipal por bradicardia
fetal, con desgarro de 3° grado y sutura sin complicaciones.
Intercurre a las 24 horas con dolor abdominal
y defensa, con radiografía de abdomen que evidencia niveles hidroaéreos y
neumoperitoneo (Foto1). Se realiza ecografía abdominal en dos oportunidades
separadas por 12hs, que informa líquido libre en espacio esplenorrenal e
interasas como únicos datos positivos. Ante persistencia del cuadro se realiza
laparotomía exploradora observándose peritonitis biliopurulenta de cuatro
cuadrantes secundaria a ulcera gástrica antropilórica de cara anterior de 6 cm.
Se realiza rafia, toma de biopsias y lavado de cavidad.
Ingresa a UTI en POP inmediato con
estabilidad HD y ventilación espontanea. Se indica transfusión de 2 UGRD en
contexto de acidosis metabólica y anemia. Se coloca acceso venoso central para
nutrición parenteral por proyección de ayuno prolongado, se inicia terapia
antimicrobiana empírica con Ceftriaxona y Metronidazol para cobertura de foco
abdominal.
Muestra buena evolución, reiniciando
alimentación oral al 5to día POP con parenteral complementaria por 72 horas.
Alta desde la UTI al 10° día POP.
Conclusiones:
La úlcera péptica
perforada en la paciente obstétrica es de presentación infrecuente, siendo
reportados entre 1 a 6 eventos cada 23.000 embarazos. La presentación clínica
resulta similar a la paciente no gestante, aunque los diagnósticos diferenciales
y asociados plantean un desafío al equipo médico.

I Lockhart(1), I
Huespe(1), C Lockhart(1), F Pálizas Jr(2), M Colombo(3), MDP Romero(3), E
Prado(1), C Casabella García(2), M Las Heras(1), I Carboni Bisso(1)
(1) Hospital Italiano De Buenos Aires. (2)
Clínica Bazterrica. (3) Instituto Universitario Del Hospital Italiano.
Introducción: Los criterios para la selección de los
pacientes con COVID-19 que más se benefician de la terapia con ECMO aún no se
encuentran definidos. Evaluamos el rendimiento de los scores predictivos de
mortalidad de los pacientes con COVID-19 en tratamiento con ECMO.
Métodos: En este estudio prospectivo se evaluaron 38
pacientes adultos con COVID-19 que recibieron tratamiento con ECMO en dos
hospitales entre marzo de 2020 y diciembre de 2021. Evaluamos la discriminación y calibración de
los scores Prediction of Death due to Severe ARDS in V-V ECMO
(PRESERVE), Respiratory Extracorporeal Membrane Oxygenation Survival
(RESP), Prediction of Survival on ECMO Therapy-Score (PRESET), Sequential
Organ Failure Assessment (SOFA) y Acute Physiology and Chronic Health
disease Classification System II (APACHE II). Además, se realizó un análisis de
costo-beneficio en función de la probabilidad de mortalidad prevista.
Resultados: El score PRESET tuvo la discriminación más
alta (AUROCs 0.81 [IC95% 0.67-0.94]) y la mejor calibración. El umbral óptimo
para esta puntuación fue 7 (sensibilidad 67 %, especificidad 89 %, accuracy 78
%). El costo por QALY en USA, ajustado a la esperanza de vida, fue superior a
UDS 100.000 en pacientes mayores de 45 años con un PRESET>10.
Conclusión: El score PRESET tuvo el rendimiento
predictivo más alto y podría ayudar en la selección del paciente que más se
beneficiaría de esta terapia altamente invasiva y que demanda gran cantidad de
recursos.
L Bujan Molins(1),
LS Maidana(1), JF Paucar Paucar(1), SD Villarroel Medonza(1), SE Giannasi(1)
(1) Hospital Italiano De Buenos Aires.
Introducción: El incremento del número de operativos y
apertura de nuevos centros con mayores recursos, permiten la posibilidad de
receptores más añosos y comórbidos que; en contrapartida, ha dado lugar a
mayores complicaciones inmediatas. El caso a continuación consta de un paciente
en postoperatorio de trasplante unipulmonar con disfunción primaria del graft
(DPG) grado 3 con requerimiento de ECMO.
Caso clínico: Masculino 67 años con antecedente de
enfermedad coronaria, ex tabaquista (90 paq/year), fibrosis pulmonar 2ª
asbestosis con O2 domiciliario en evaluación de trasplante pulmonar. Se realiza
trasplante unipulmonar izquierdo de donante fememino 19 años. Tiempo de
isquemia 6 hs.
Durante las primeras 24 hs evoluciona con
cuadro de hipoxemia severa con PAFI < 150 refractaria a ventilación
ultraprotectiva, uso de Bloqueantes neuromusculares y administración de óxido
nítrico inhalado; se evidencia progresión de infiltrados bilaterales en
radiografía de tórax (Figura 1). Se interpreta como DPG grado 3 por lo que se
decide colocación de ECMO Veno-Venoso Femoral/Yugular.
Discusión: La DPG está presente entre el 20-30% de los
pacientes, presenta su clasificación a partir de la escala de International
Society for Heart and Lung Transplantation que permite establecer grado de
severidad y predicción de la morbi-mortalidad a corto plazo.
La ventilación protectiva ajustada al peso
predicho del donante, weaning y extubación temprana serían ideales para
minimizar la injuria inducida por la ventilación mecánica invasiva (VILI) y son
la base del manejo postoperatorio.
La tabla 1 resume de manera esquemática el
manejo inicial y plan terapéutico ante hipoxemia progresiva como es el caso
DPG. Ante refractariedad el uso de bloqueante neuromusculares, maniobra de
prono, Óxido nítrico inhalado y colocación de ECMO serán indicados según corresponda.
No cabe duda que ante DPG severa refractaria
con progresión de hipoxemia la indicación de ECMO es acertada para prevenir
mayor VILI y toxicidad por oxígeno en un pulmón trasplantado ya injuriado.
Conclusión: Entre las complicaciones del trasplante de
pulmón la DPG presenta impacto en la morbi-mortalidad y sobrevida del paciente
trasplantado. En caso de progresión a hipoxemia refractaria la utilización de
ECMO como soporte pareciera ser la última herramienta eficiente ante tal
situación crítica.


0034 LA GRAVEDAD DEL SDRA
INTERFIERE CON EL VALOR CLÍNICO DE LA POTENCIA MECÁNICA
N Pistillo(1), P
Castelluccio(1), I Suzuki(1)
(1) El Cruce.
Objetivo: Evaluar cuanto influye la gravedad del SDRA
sobre el riesgo de VILI, en pacientes ventilados bajo similar carga del sistema
respiratorio.
Materiales y Método: El trabajo fue aprobado por la institución y
se solicitó consentimiento informado a los familiares. ClinicalTrials.gov:
NCT05410262.
Procedimiento: Se evaluaron prospectivamente y de manera
consecutiva pacientes con SDRA. Se excluyeron: EPOC, pacientes severamente
inestables, obesos mórbidos, moribundos y embarazadas. Los pacientes fueron
ventilados transitoriamente en VCV, con similar Vt (6 mL/kg/PBW), PPlat (30 cmH
2O) y frecuencia respiratoria (15
ciclos/min). La PEEP se ajustó para obtener la PPlat objetivo. Se midieron
variables de mecánica ventilatoria incluyendo presiones transpulmonares.
Simultáneamente se realizó una TAC de tórax en inspiración y espiración. Se
analizaron densidades y volúmenes pulmonares con un software específico.
Se calculó la potencia mecánica del sistema
respiratorio (PMSR) según la siguiente ecuación:
PM=0.098 x RR x {Vt2 x [1/2 x Ers+RR x
((1+I:E))/(6 x I:E) x Raw ]+ Vt x PEEP}. También se calculó la potencia mecánica
transferida al pulmón (PML) sustituyendo presiones sistémicas por equivalentes
transpulmonares. La PML se normalizó al volumen del pulmón ventilable (PM
Normalizada= PML/EELV).
Se definió strain a la proporción entre Vt y
el EELV, aceptando que el volumen PEEP transfiere carga a los alvéolos (energía
potencial). Consideramos atelectrauma a la diferencia de pulmón no aireado
entre ambos tiempos ventilatorios.
Resultados: Se estudiaron 18 pacientes (Femenino: 5),
edad: 34 (29-47 años), APACHE II: 20.5 (19-22 puntos), PaO2/FiO2: 158
(124-202), CSR: 24 (21-27 mL/cmH2O), Vt: 385 (350-420 mL), PEEP: 14 (12-16
cmH2O), ΔP: 16 (14-18 cmH2O), mortalidad: 28%. Aunque
la PMSR fue similar entre los pacientes 23.7 (23.3 – 24.5 J/min/L), la carga
aplicada sobre el pulmón ventilable aumentó proporcionalmente con la gravedad
del SDRA, de manera tal que los pacientes con SDRA severo recibieron casi el
triple de potencia que aquellos con compromiso leve (Panel: A). Este aumento
relativo de la carga por “unidad alveolar”, se relacionó con niveles más altos
de estrés, strain y atelectrauma (Paneles: B, C y D). Conclusiones: Similar PM
SR puede tener consecuencias diferentes a
nivel pulmonar dependiendo de la gravedad del SDRA.

0035 Coma Mixedematoso con
insuficiencia cardíaca aguda en su presentación: Reporte de caso
J Montesinos(1), J
Gutierrez(2), F Mejía(2)
(1) Sanatorio Güemes. (2) Sanatorio Güemes /
Uba.
Introducción: El término coma mixedematoso (CM) resulta
engañoso. Se presenta como alteración del estado mental, hasta el coma, puede
no encontrarse edema con fóvea. En Argentina, una serie de 27 pacientes solo
29% tenía Glasgow 3/15, la incidencia (2017) fue de 0.22/millón. La mortalidad
histórica mundial era del 60-80% con descenso progresivo hasta el 20%-25%.
Los pilares del tratamiento: Soporte vital,
repleción de hormonas tiroideas y corticoides (Asociación con insuficiencia
suprarrenal) disminuyen la mortalidad. Este caso ilustra la importancia del
diagnóstico adecuado.
Presentación: Paciente masculino de 44 años. Antecedentes
(Datos posteriores): Vitíligo, hipotiroidismo (Sin tratamiento) Insuficiencia
suprarrenal (2016).
Ingreso: GCS 3/15, taquicardia e hipotensión.
Presunción diagnóstica: Shock séptico, vasoactivos a altas dosis. Se realiza
IOT/ARM. Inicia corticoides. Estudios: TC: Encéfalo, tórax y abdomen: Sin
patología.
Mayor requerimiento de vasoactivos. Sospecha
de Shock mixto vs cardiogénico: ECOTT: Trastorno de motilidad anteroseptal,
medial y basal, FSVI Moderado, VTI 9.6 TSVI 6,7 FC 90, GC 3.02, EAB PH 7.49
PCO2 27.4 HCO3 20 DCO2 11 Cooximetría 41% Lactato 3.2, ProBnp >35.000, ECG:
Normal. Inicia Dobutamina, Levotiroxina 200mcg vía oral, posteriormente
endovenosa, T3 20mcg/kg/min e Hidrocortisona 100mg c/8 horas.
Al control, ECOTT: VTI 12 TSVI 5 FC 110 GC
6.6, EAB: PH 7.43 PCO2 30 HCO3 20 DCO2 7 Cooximetría 64% Lactato 2,3. TSH >
100 T4T 1.1 T4L 0.12 T3 47.5 Cortisol >63. Diagnóstico: Coma mixedematoso
con compromiso cardíaco. Control T4L: 0.9 T3: 1.9. Evoluciona favorablemente:
Sin vasoactivos, weaning exitoso, asintomático, se da su pase a sala general y
posterior alta.
Discusión: El coma y
shock como presentación inicial representa un reto diagnóstico. Una adecuada
anamnesis (Fuente confiable) cambia el desenlace. La pobre adherencia al
sistema de salud y medicación, condiciona mayor morbimortalidad, afectación
cardíaca: Bajo gasto cardíaco, menor contractilidad, volumen minuto, arritmias
e incluso derrame pericárdico. Este caso demuestra cómo el tratamiento
oportuno, revierte esta afectación y mejora el pronóstico.
Conclusión: Se demuestra la importancia de reconocer el
hipotiroidismo severo o el coma mixedematoso como un causa de shock y
alteración de la conciencia, incluso en pacientes jóvenes. Dada la mortalidad y
complicaciones hemodinámicas. El tratamiento apropiado, reduce el tiempo de
soporte vital, la estadía en terapia intensiva y mejora el pronóstico.
0036 LESION ESPLENICA
SECUNDARIA A VIDEOCOLONOSCOPIA
A Gira(1), R
Almanza(1), P Falvo(1), D Monardo(1), P Pratesi(1), M Ugarte(1)
(1) Universitario Austral.
Introducción: La incidencia del trauma esplénico es del
30-45%, del iatrogénico secundario a Videocolonoscopia es del 0,5% y mortalidad
del 5%.
El mecanismo del trauma incluye, tracción
excesiva en los ligamentos esplenocolico por endoscopio, escasa movilidad del
bazo por adherencias al colon, maniobras de avance en sigma .
Diagnostico por: Lavado peritoneal , Eco
FAST: no predice origen del sangrado, TC abdominal con contraste EV: Identifica
pseudoaneurismas, sangrado activo , Hematoma S:99%.
El bazo conserva su funcion con una masa
critica >50%
Presentación del caso: Paciente de sexo femenino de 59 años, con
antecedentes de Obesidad, HTA
Se realiza VCC para screening de Cancer de
colon, se resecan 2 pólipos y alta medica
A las 48 hs ingresa por guardia con dolor
abominal, hemodinamicamente estable, tomografia de abdomen evidencia hematoma
subcapsular esplénico (>50%) y laceración del parénquima de 18 mm e
hiperdensidad en polo superior sugestivo de sangrado activo (Lesion grado IV
según Asociacion Americana de cirugía del trauma).
Ingresa a UCI hemodinamicamente estable, a
las 24 hs tomografía de abdomen evidencia disminución de hematoma sin sangrado
activo, a las 72 hs pasa a clínica medica .
Discusión: Se podría realizar tratamiento conservador no
operatorio, en el traumatismo no penetrante, estabilidad hemodinámica, lesión
esplénica única, transfusión <2 UGRS , La embolizacion es beneficiosa con
lesiones Grados : III,IV,V, la cirugía se indica en inestabilidad hemodinamica
Conclusiones: La incidencia de trauma esplénico iatrogénico
esta subestimada debidoquizas a escaso registro
Considerar tratamiento no operatorio en
centros con monitorización continua, evaluación clínica seriada y
disponibilidad de equipo quirúrgico.
0038 TOXICIDAD Y FALLECIMIENTO
DE 2 PACIENTES POR CONSUMO DE THEVETIA AHOUAI EN NORTE DE SANTANDER
LA Dulcey
Sarmiento(1), JS Theran Leon(2), R Caltagirone(3), IC Assaf Seguias(3), V
Cabrera Peña(1), AL Ruge Serrano(4), JA Pineda Parada(3), JJ Barbosa Del
Castillo(1), MJ Aguas Cantillo(2), RG Parales Strauch(1), A Quintero Romero(4)
(1) Universidad Autonoma De Bucaramanga. (2)
Universidad De Santander. (3) Universidad De Los Andes. (4) Universidad
Metropolitana.
Introduccion: La planta catape roja, Familia Apocynaceae,
Nombre científico Thevetia ahouai es de uso ornamental, sin embargo sus efectos
tóxicos son poco conocidos. Esta planta tiene entre sus principales activos los
glucósidos cardíacos y las semillas tienen el mayor porcentaje de estos. Otro
de sus efectos es el diurético, que puede ser excesivo y provocar graves alteraciones
hidroelectrolíticas. Las semillas mantienen su toxicidad al estar deshidratadas
y el riesgo de intoxicación es mayor cuanto menos maduro está el fruto. Las
alteraciones ácido-base también son frecuentes.
Objetivos: Describir 2 casos de intoxicación con
mortalidad asociada al consumo de estas bayas en Norte de Santander.
Presentacion del caso: Se revisaron las historias clínicas de 2
pacientes pediátricos sin ninguna enfermedad previa atendidos en 2021 que
consumieron bayas rojas silvestres de catape. A las 12 horas presenta
alteración de la conciencia, acidemia, insuficiencia renal, insuficiencia
hepática y requerimiento de terapia de reemplazo renal. Los gases arteriales
mostraron pH menor de 7,1 en ambos casos. El nivel de conciencia era inferior a
8 puntos según la escala de Glasgow en los 2 pacientes. La enfermedad en los 2
pacientes fue rápidamente progresiva con mortalidad en las primeras 48 horas.
Discusion: Existen pocas descripciones en la literatura
de intoxicaciones por las plantas de la familia Apocynaceae o Thevetia ahouai,
en las bibliotecas de literatura científica solo aparecen 59 artículos en el
buscador pubmed a la fecha de envío de esta comunicación. No existe un antídoto
específico y las medidas están dirigidas al apoyo general. Se ha informado que
el carbón activado aumenta la eliminación de estos cardenólidos. Las
bradiarritmias se pueden tratar con atropina, isoprenalina o marcapasos
temporal.
Conclusiones: Hay muchas toxinas no descritas que se
encuentran en las plantas hasta el momento, y se debe fomentar la investigación
en esta área toxicologica.

LA Dulcey
Sarmiento(3), LA Dulcey Sarmiento(1), JS Theran Leon(2), R Caltagirone(3), MJ
Aguas Cantillo(2), F Rangel(4), RG Parales Strauch(1), V Cabrera Peña(1), A
Quintero Romero(5)
(1) Universidad Autonoma De Bucaramanga. (2) Universidad
De Santander. (3) Universitario De Los Andes. (4) Universidad Industrial De
Santander. (5) Universidad Metropolitana.
Introducción: La neumonía asociada a la ventilación
mecánica acarrea una gran morbimortalidad en presencia de gérmenes con resistencia
extendida por mecanismos moleculares y genéticos.
Objetivo: Determinar el perfil microbiológico de las
neumonías asociadas a la ventilación mecánica en pacientes de un hospital de IV
nivel y caracterizar microbiológica y genéticamente las cepas de resistentes a
los β-lactámicos y
carbapenémicos aisladas en pacientes con esta patología.
Materiales y métodos: Se obtuvieron 73 muestras de secreción
bronquial de pacientes con neumonia durante el período enero a diciembre de
2016. Las cepas aisladas fueron identificadas con el sistema VITEK 2 y las
pruebas de susceptibilidad fueron determinadas por concentración inhibitoria
mínima. El análisis molecular de los genes codificantes para B-lactamasas de
espectro extendido y carbapenemasas se realizaron por amplificación de PCR.
Resultados: Los patógenos más frecuentes en neumonia
asociada a la ventilación mecánica fueron las enterobacterias. Estas últimas
agruparon diferentes tipos de BLEEs y carbapenemasas.
Discusion: El análisis de las relaciones genéticas de
las cepas de E. coli y K. pneumoniae reveló que en ambos grupos bacterianos se
concentraron mayoritariamente en el área de emergencia adultos. Este hallazgo
indica que esta área se comporta como el principal nicho para el intercambio y
recombinación de genes codificantes para BLEE y carbapenemasas en bacterias
Gram-negativas y representa el área de mayor riesgo y distribución de clonas
multirresistentes.
Conclusión: Las neumonías asociadas a la ventilación
mecánica son un problema bastante frecuente en las unidades de cuidado
intensivo más aun aquellas que incluyen gérmenes con factores de virulencia
como lo son aquellas productoras de Betalactamasas y Carbapenemasas. Se
evidencia la necesidad urgente de implementar programas para prevenir y controlar
la diseminación de clonas bacterianas multirresistentes, así como establecer
estrategias efectivas que permitan racionalizar el uso de los antimicrobianos.
0040 Composición del gasto en
la UTI del Hospital Italiano de Rosario, en un período de 6 meses
E Vera(1), R
Pellini(1)
(1) Hospital Italiano Rosario.
Se analizó la composición del gasto económico que se generó en la
Unidad de Terapia Intensiva del Hospital Italiano de Rosario, expresándola en
términos porcentuales, entre los meses de Noviembre de 2021 y Abril de 2022, y
clasificándola en tres Rubros principales: Medicamentos; Descartables e
Insumos; y Alimentación. Además se determinó el perfil de la sala en esos meses
tomando como indicadores: la ocupación, los días de Ventilación Invasiva, el
tipo de patología al ingreso (Clínica, Quirúrgica y Cardiológica). Se
excluyeron en el análisis gastos administrativos (sueldos y jornales del
personal médico y no médico, consumo de oxígeno, material protésico).
Los resultados fueron los siguientes: Hubo 2165 días de ocupación
(66%) en 6 meses. De esos días el 66% fueron pacientes Clínicos, el 28%
Quirúrgicos y el 6% Cardiológicos (camas prestadas a la Unidad Coronaria ante
saturación de la misma). De la totalidad de días, el 47% fueron días de Ventilación
Invasiva. La composición del gasto fue: 74% en el rubro Medicamentos; 23%
Descartables e Insumos y 3% Alimentación. Del total del gasto en el Rubro
Medicamentos, los tres subrubros de mayor gasto fueron: 18% en Medicamentos de
Alto Costo (Gammaglobulina Humana, Anfotericina B liposomal y
Ceftazidima/Avibactám); 16% en Heparinas; y 15% en Sueros. Del total del gasto
en el Rubro Descartables e Insumos los tres subrubros de mayor gasto fueron:
34% Elementos de Higiene, Asepsia y Antisepsia; 24% Anexos de arterio y
venopunción; y 14% Catéteres (vasculares y no vasculares); Del total del gasto
en el Rubro Alimentación, la composición de los subrubros fue: 71% en
Alimentación enteral y 29% parenteral.


0041 Traqueostomía en pacientes
con COVID-19 ¿la disfagia condiciona el tiempo de decanulación?
ME Catini(1), A
Falduti(1), G Chiappero(1)
(1) Juan A Fernandez.
Introducción: la disfagia orofaríngea es un síntoma
frecuente en pacientes con cánula de traqueostomía (TQT). En nuestro país, alrededor
de un cuarto de los pacientes con COVID- 19 requirieron TQT por ventilación
mecánica prolongada.
Objetivo: describir la frecuencia de disfagia
orofaríngea en una serie de pacientes críticos con COVID 19, su asociación con
variables clínico-demográficas y días de TQT.
Material y métodos: estudio observacional, longitudinal y
retrospectivo, realizado en el Hospital Juan A. Fernández, entre Mayo de 2020 y
Diciembre de 2021. Se incluyeron de manera consecutiva pacientes
traqueostomizados con diagnóstico de COVID-19. La presencia de disfagia
orofaríngea se valoró mediante estudio endoscópico de la deglución (FEES) al
momento de la decanulación. Se considero disfagia a un puntaje mayor o igual a
2 puntos de la Escala de Penetración Aspiración para la consistencia semisólida
y/o líquidos.
Resultados: Se realizó FEES a 65 pacientes, de los cuales
50 (76,9 %) presentaron disfagia para la consistencia semisólida y/o líquidos.
(Figura 1) La mediana de edad en pacientes sin disfagia fue de 51 (RIQ 43 - 60)
años; en los que presentaron disfagia fue de 62 (RIQ 51.5 - 70.25) años,
observándose una diferencia significativa entre grupos (p:0,045%). (tabla 1).
La mediana de días de TQT fue de 32 (RIQ 21 - 60.5). Al comparar los días de
TQT entre el grupo sin disfagia y con disfagia se observó diferencia
estadísticamente significativa entre ambos grupos (p=0.015); mediana 21 (RIQ 17
- 33) días vs mediana 36 (RIQ 21 - 63.75) días. La mediana de días del proceso
de decanulación fue de 7 (RIQ 3.5 - 30) días. En pacientes sin disfagia la
mediana de días hasta la decanulación fue de 4.5 (RIQ 3 - 7) días en
comparación a 11 (RIQ 4 - 34) días en el grupo con disfagia, encontrándose una
diferencia estadísticamente significativa (p=0.017).
Conclusión: La disfagia orofaríngea fue prevalente en
nuestra serie de pacientes, prolongando la cantidad de días de TQT hasta la
decanulación. La utilización de un método instrumental de evaluación nos ha
permitido detectar precozmente la disfagia y planificar un tratamiento
oportuno.


SI Ramos
Elizagaray(1), F Asenatto(1), LH Llano Lopez(1)
(1) Notti.
Introducción: La necrólisis epidérmica tóxica es un cuadro
sistémico caracterizado por destrucción y desprendimiento agudo de la piel de
causa inmunológica, frecuentemente asociado a fármacos, con respuesta variable
al tratamiento con corticoides, inmunoglobulinas y/o plasmaféresis.
Presentación de caso: Paciente de 10 años de edad, sexo femenino,
que se internó por vómitos, diarrea, fiebre y erupción cutánea de 48 hs de
evolución. Se constató exantema exfoliativo ampollar generalizado con
compromiso de genitales, signo de Nicolsky+, inyección conjuntival con
secreción purulenta y queilitis. Evolucionó desfavorablemente las siguientes 24
horas, decidiendose su ingreso a terapia intensiva (UTIP) por shock
distributivo. Requirió 8 días en AVM y 5 días de inotrópicos. No se obtuvo
identificación de germen por cultivos, detectando IgM e IgG positivas para
Mycoplasma pneumoniae y Anticuerpos Anti SARS COV-2 positivos. Las lesiones
epidérmicas progresaron hasta afectar un 65% de superficie corporal, por lo que
recibió tratamiento con gammaglobulina 1 gr/kg/día por 3 días (1º, 2º y 4º día),
metilprednisolona 1 mg/kg/día (desde día 3 hasta día 14) y ciclosporina 3
mg/kg/dia (del 4º al 47º día). El tratamiento tópico se realizó con plasma de
convaleciente rico en plaquetas (PRP) aplicado mediante goteo en 4 sesiones
(días 4, 6, 8 y 10), manteniendo durante ese tiempo un halo de acrílico para
mantener la humedad de la piel, apósitos parafinados y vendajes estériles.
Egresó de UTIP luego de 14 días de internación y externación hospitalaria a los
20 días con reepitelización de un 80% de la superficie corporal.
Discusión: La aplicación tópica de PRP ha demostrado ser
útil en medicina regenerativa, otorgando beneficios en la cicatrización de
heridas. La técnica de preparación y administración aún está en discusión. En
nuestro caso, se administró plasma de donante tratado con gluconato de calcio
al 10% (a fin de estimular la liberación de factores de crecimiento),
almacenado a 20º.
Conclusión: La necrolisis epidérmica tóxica es una rara
patología en niños. En nuestro caso, la aplicación de plasma rico en plaquetas
resultó en una significativa reducción del tiempo de regeneración de la piel,
sin complicaciones ni secuelas y con breve estancia hospitalaria.

E Martinez(1), C
Aguilera(2), D Marquez(2), V Sturzenegger(3), C Cimino(3), E Hidalgo(2), H
Escobar(3), S Piombi Adanza(2), G Zielger(3), L Tschopp(3), C Cominotti(3), J
Plumet(3), C Pereyra(3)
(1) Trinidad Ramos Mejía. (2) Juan A.
Fernández. (3) Sanatorio Trinidad Ramos Mejía.
Introducción: Hay escasa información sobre los resultados
de pacientes con COVID-19 que requirieron ventilación mecánica invasiva (VMI)
durante la tercera ola.
Objetivos: Determinar la mortalidad hospitalaria y
explorar los resultados funcionales y cognitivos a 30 días del alta
hospitalaria de pacientes con COVID-19 que requirieron VMI en dos centros del AMBA.
Métodos: Estudio de cohorte prospectiva. Se incluyeron
pacientes >18 años con COVID-19 que requirieron VMI. Evento primario:
mortalidad hospitalaria. Eventos secundarios: Dependencia física
(Barthel<100) y deterioro cognitivo (MOCA<26) a 30 días del alta
hospitalaria.
Resultados: Entre 1/12/2021 y 30/05/2022 se incluyeron 33
pacientes con COVID-19. La mediana de edad 69 años (59–74). 24(72%) hombres;
23(70%) obesos, 11(33%) diabéticos, 19(57.5%) hipertensos, y 24(72%) fueron
vacunados. La mediana de Apache II 19(16–24) y SOFA 8(6–8). Utilizaron
vasopresores 31(94%) y 20(60.6%) recibieron decúbito prono. La mortalidad
intrahospitalaria y en UCI fue 36.36%(11/33 pacientes). La regresión de Cox
identificó a la diabetes (HR: 6.97 (1.8-26.3)) y el Apache II (HR: 1.18
(1.07–1.30)) como predictores independientes de mortalidad
(discriminaciön:Harrell’s C:0.83).
Sobrevivieron 19 pacientes sin afección
cognitiva y física previa. La mediana de días de internación en UCI y el
hospital fue de 48 días (40-58) y 60 días (50-63) respectivamente. 15 pacientes
(79%) requirieron traqueostomia y 9(47 %) fueron a centro de rehabilitación. A
30 días del alta 13 pacientes (68 %) presentaron dependencia en actividades de
la vida diaria con una mediana del Barthel: 30(20-100) y 7 (39 %) presentaron
deterioro cognitivo con una mediana de MOCA: 26(21-18). Los pacientes
dependientes fueron más obesos (84% vs 33%, p: 0.04) tuvieron más días de VMI
(42 días (38-54) vs 30 días (7-37), p: 0.012), mayor Apache II (20(18-24) vs
13(13-16), p: 0.013) y más días de vasopresores (12 días (8-19) vs 4 días
(1-6), p: 0.02).
Conclusiones: En nuestro estudio la mortalidad fue menor
que la reportada en las primera ola. Podría deberse a la vacunación con la
disminución de casos y menor carga de trabajo. La diabetes y el Apache II se
asociaron independientemente a la mortalidad. Un 68 % de los sobrevivientes
presentaron dependencia funcional. Estos datos permiten empezar a conocer el
impacto post COVID-19 en la salud de los pacientes en nuestro país.


0045 NORSE (New onset
refractory Status Epilepticus) causada
por micosis profunda (Feohifomicosis)
A Gira(1), A
Figueroa(1), G Mast(1), R Andrade(1), P Pratesi(1)
(1) Universitario Austral.
Introducción: El Status super refractario definido por
persistencia de actividad electroencefalografica a pesar del uso de tercera
línea de tratamiento. La etiología frecuente es estructural e infecciosa
neurológica.
En 2018 se define NORSE (New Once Refractory
Status Epilepticus) estado epiléptico refractario sin epilepsia activa o
patología neurológica preexistente y sin un cuadro agudo estructural, toxico o
metabólico. El 50% es criptogenica y el resto por encefalitis autoinmune e
infecciones sistémicas virales y micoticas.
Las feohifomicosis son causadas por hongos
negros con alto neurotropismo pero no se aislan en LCR
Caso clínico: Mujer de 54 años, trasplantada renal,
medicada con inmunosupresores.
Ingresa por guardia con fiebre, diarrea y
convulsiones, se realiza Tc cerebro sin lesión y Tc tórax con infiltrados
bilaterales, Punción Lumbar (Leucocitos 63, Monómeros 80%) inicia
Antimicrobianos, requiere ARM bajo sedoanalgesia y anticomiciales, se realiza
BAL y EEG sin descarga.
Al tercer dia Status convulsivo se aumenta
dosis de sedación y 4 anticomiciales, presenta status por 7 dias, con cultivo
de LCR negativo.
A los 10 días del BAL se aísla Feohifomicosis
e inicia Voriconazol y a las 48hs EEG sin descargas. RMN de cerebro con
hiperintensidad frontal derecha. A los 45 días pasa a clínica medica.
Discusión: Ante la sospecha de NORSE solicitar en LCR:
cultivos bacteriano, viral, Mycoplasma, LCR y suero: AntiNMDA, AntiVGKC,
antiAMPA, antiGABA y en suero: ANA, ANCA, AntiRo, AntiLa, Antitiroideos,
AntiScl70 .
Conclusión: En status convulsivo el diagnostico se
centraliza en estudios del cerebro que en este caso fueron no concluyentes y la
búsqueda de focos alternativos nos permitió identificar la etiología y
considerarlo NORSE.
VP Lobo(1), M
Isa(1), JE Perez Romero(1), RA Dilaccio(1)
(1) Clínica Regional Del Sud.
Introducción: La colocación de acceso venoso central es un
procedimiento invasivo que contempla posibles complicaciones que deben de ser
explicadas al paciente mediante consentimiento informado al paciente y
familiares.
La técnica a utilizar puede ser la
convencional con Técnica de Seldinger que recurre a la anatomía del acceso
venoso central a utilizar; como ser de acceso venoso central yugular o acceso
venoso central subclavio versus la utilización de técnica de inserción guiada
por ecografía en los accesos antes mencionados.
Materiales y Métodos: Se realizó un estudio descriptivo,
prospectivo desde mayo del 2022 hasta junio del 2022 del Servicio de Terapia
Intensiva de la Clínica Regional del Sud, Río Cuarto, Córdoba, Argentina de
donde se recolectaron datos de los ingresos a dicha unidad que requirieron
colocación de catéter venoso central.
Resultados: Diferenciamos las complicaciones agudas más
frecuentes en relación a la técnica utilizada durante el procedimiento invasivo
englobando a los 21 pacientes que requirieron dicho procedimiento dentro de
nuestra institución obteniendo resultados de: Técnica convencional de
colocación de acceso venoso central con n=6; presencia de sangrado en 1/6 que
equivale al 17% (p0.03); Hematoma en 1/6 siendo el 17% (p0.03); Neumotórax 1/6
siendo el 17% (p0.03) e Infección 1/6 con el 17 % (p0.03). Técnica realizada
bajo seguimiento ecográfico representó una n=15, en donde se objetivo sin
presencia de sangrado relacionado al procedimiento; Hematoma 2/15 con el 13%.
Conclusión: El estudio si bien no marca relevancia en
cuanto a la bibliografía descrita en relación al tema, es de mucha ayuda a
nivel institucional, ya que nos encontramos con la limitante de que no todos
los profesionales que ejercen su actividad en la misma se encuentran debidamente
entrenados para utilización del método guiado por ecografía o se sienten
cómodos por su formación en la colocación de este tipo de procedimientos
invasivos de forma convencional. Por lo que nos brinda punto de apoyo para
reivindicar el método de colocación de vía endovenosa con acceso central guiado
por ecografía. Siento este, aunque no exento de complicaciones, el mejor método
para realizar este tipo de procedimiento.
M Castillo
Ortega(1), FA Sosa(1), J Weight(1), A Matarrese(1), JJ Ruiz(1), G Paz(1), J
Osatnik(1), M Kleinert(1), G Cesar(1), D Ivulich(1), P Merlo(1)
(1) Aleman.
Introducción: Durante la pandemia de COVID-19, muchos
pacientes con distress respiratorio del adulto (SDRA) se presentaron con severa
alteración del intercambios gaseoso, requiriendo además de estrategias
ventilatorias protectivas y titulación de PEEP, decúbito prono por tiempos
prolongados. Estos pacientes pueden presentar disfunción ventricular aguda con
alteraciones hemodinámicas y más aún cuando requieren terapia vasopresora a
altas dosis. La valoración por medio de la ecocardiografía transesofágica (ETE)
es una herramienta considerada por muchos como gold standard para valorar la
hemodinamia en pacientes ventilados en decúbito prono.
Materiales y método: Cohorte prospectiva de pacientes admitidos a
la UCI con SDRA, desde el 20 de junio de 2020 hasta el 20 de septiembre de
2021. Se incluyeron pacientes > de 18 años de edad, con AVM, en decúbito
prono, con PAFI < 150. Se realizó un ETE dentro de las 24 horas de la
colocación en decúbito prono (DP). Pacientes con RASS -4, con analgosedación y
relajantes musculares. Se analizaron variables clínicas como edad, sexo,
comorbilidades, gravedad al ingreso por APACHE II, días en UCI y hospital y
mortalidad en UCI.
Resultados: 355 pacientes ingresaron a UCI con
diagnóstico de covid-19 por PCR, 202 (57%) requirieron AVM. 92 (46%)
requirieron DP.
Encontramos baja prevalencia de disfunción
ventricular izquierda severa (1%) medido por método de Simpson biplano.
Disfunción ventricular derecha valorada a través del CFA (anormal < 35%) en
21 casos (24%), cor pulmonar agudo (VD/VI > 1 y presencia de aplanamiento
septal) en 36 ( 41%) pacientes. No hubo complicaciones asociadas para el
paciente, ni contagios en el personal médico.
Conclusión: El COVID-19 ha colocado a las UTI ante un
cambiante desafío. La importancia de la valoración hemodinámica durante la AVM
en DP a puesto a la valoración transesofágica como una herramienta de
indispensable valor.
Sin bien la inestabilidad hemodinámica
presentada por los pacientes con cor pulmonar agudo en nuestra serie fue
notoria y nos permitió realizar cambios para aliviar las presiones en el
corazón derecho, todavía faltan estudios con significancia estadística que nos
respondan sobre su verdadero valor pronóstico en el escenario del distress
respiratorio.
0048 SINDROME COMPARTIMENTAL
ABDOMINAL POR SARCOMA DEL ESTROMA
ENDOMETRIAL
JJ Madera(1), M
Lanci(1), J Marchetti(1), C Hernandez(1), G Guerrero(1), N Grubissich(1), C
Rollano(1), T Negreira(1), H Cacone(1), J Aguilar(1), M Steinhaus(1), P
Boschini(1)
(1) Hospital Angel H Roffo.
Introducción: El sarcoma de estroma endometrial comprende
el 1% de los tumores malignos ginecológicos y es causa poco frecuente de
sindrome compartimental abdominal.
Presentación del caso: Femenina, 32 años con dolor en hipogastrio
mas metrorragia. Legrado endocervical y Cepillado: Sarcoma del Estroma
endometrial de alto grado, tratamiento oncoespecífico:
Epidoxorubicina+Ifosfamida y posteriormente Gemcitabina+Docetaxel. 22/05/2022
Internación en Instituto Roffo en plan quirúrgico de citorreducción,
presentando tos y fiebre al segundo día de internación, PCR COVID 19 negativo.
Se diagnostica Neumonía adquirida en la comunidad. Inicia ampicilina sulbactam
y oseltamivir , evolución desfavorable , ingreso a terapia intensiva el 26/05/2022
por insuficiencia ventilatoria en contexto de presión intraabdominal inicial de
20mmhg, requiriendo asistencia ventilatoria mecánica . Posteriormente progresa
a sindrome compartimental abdominal por presión de 30mmhg mas falla
hemodinámica, requerimiento soporte vasoactivo con Noradrenalina. Tomografía
computada de abdomen y pelvis evidencia componente quístico septado ocupando
toda la cavidad abdominal. Se realizó drenaje percutaneo ecoguiado con descenso
progresivo de la presión intraabdominal, resolución de sus fallas orgánicas con
extubacion a los 11 días.
07/06/2022 Anexohisterectomia + Omentectomia
, recuperación en Unidad de Terapia intensiva bajo asistencia respiratoria
mecánica hasta extubacion el 12/06 ,egreso el 24/06/2022
Discusión: La hipertensión intraabdominal producida por
el componente quístico gigante , produjo el desplazamiento hacia cefálico del
diafragma provocando la disfunción respiratoria caracterizada por aumento de
las presión intratoracicas, mientras que a nivel cardiovascular la disminución
del gasto cardiaco y contractibilidad ventricular llevan a la falla
hemodinamica. La disminución de la presión intraabdominal provoco la mejoria de
la compliance pulmonar y la mejoría de la función sistolica.
Conclusión: El sarcoma de
estroma endrometrial de comportamiento agresivo asociado al marcador
inmuohistoquimico Ciclina D1 , puede presentarse con un componente quístico
gigante , favoreciendo el desarrollo del sindrome compartimental abdominal. La
resolución de esta complicación mejora las posibilidades de alcanzar un
tratamiento quirúrgico que ofrece un indice de supervivencia a los 3 y 5 años
de 49.8% y 31.1%, obligando a replantearnos nuestra conducta frente a
determinados pacientes oncologicos.


L Juarez
Gastiazoro(1), C Nestor Ivan(1), R Nadia(1), F Anabella(1), R Tamara(1), B
Maria Luz(1), C Leandro(1), H Marcos Emilio(1)
(1) Sanatorio Diagnostico.
Introducción: Las microangiopatías trombóticas (MAT) se
definen por trombocitopenia, anemia hemolítica microangiopática y disfunción de
órganos; las entidades más frecuentes de este grupo son el síndrome urémico
hemolítico (SUH), la púrpura trombocitopénica trombótica (PTT) y el síndrome de
HELLP.
El síndrome urémico hemolítico atípico (SUHa)
se asocia al embarazo, como factor desencadenante. Muchas veces en
concomitancia con síndrome de HELLP; dada la mayor frecuencia de este último,
resulta desafiante su diagnóstico diferencial.
Presentación del caso: Paciente femenina de 31 años, cursando
embarazo de 34 semanas. Ingresó a UTI en el postoperatorio de cesárea por
síndrome de HELLP; hipertensa (220/130 mmHg), creatinina 1,9 mg/dL, plaquetas
45.000/mm3, bilirrubina indirecta 2,14 mg/dL y LDH 4267 UI/L.
Evolucionó en anasarca, falla renal (AKIN
III), orina completa sin proteínas, frotis de sangre periférica con 2%
esquistocitos, sin alteraciones neurológicas. Se inició hemodiálisis.
Sin mejoría, se realizó biopsia renal y se
solicitó ADAMTS 13 y Anti-ADAMTS 13.
El duodécimo día presentó anemia hemolítica
severa (Hb 4 mg/dl), TP y KPTT normales, insuficiencia respiratoria y shock
refractario, se descartó hemorragia activa. A pesar de la reanimación falleció.
Discusión: En nuestro caso, se sospechó inicialmente
HELLP por presentar los pilares diagnósticos básicos de esta entidad. Sin
mejoría del cuadro hematológico y persistiendo la necesidad de hemodiálisis,
planteamos nuevos diagnósticos. Se solicitó medición de ADAMTS 13 y anti-ADAMTS
13, y biopsia renal.
Luego de un periodo de estabilidad, la
paciente presenta empeoramiento brusco de su anemia hemolítica, SDRA, shock
refractario y sin posibilidad de realizar plasmaféresis, por el compromiso hemodinámico
fallece.
Post mortem, la anatomía patológica informó
lesiones glomerulares compatibles con MAT y depósito de fibrinógeno en
arteriolas aferentes; ésto, sumado a anemia hemolítica, trombocitopenia y falla
renal progresiva, en paciente con HELLP que ingresa con creatininemia superior
a 1.9 mg/dL y LDH mayor a 1832 U/L son característicos del SUHa.
Conclusión: Las pacientes con síndrome de HELLP, sin
mejoría una vez interrumpido el embarazo, progresión de la anemia hemolítica
microangiopática, disfunción de órganos y umbrales de laboratorios
característicos (creatinina ≥1.9 mg/dl, LDH ≥1832 U/L) debemos sospechar SUHa,
para realizar, tempranamente, medidas diagnóstico-terapéuticas adecuadas y
evitar un desenlace fatal.
P Delgado(1), V
Mercado(1), G Granado(1)
(1) Clinica Pasteur.
Fue en el año 1971 la primera publicación en
el NEJM por el Dr. JD Hill con uso de lo que hoy conocemos como membrana de
oxigenación extracorpórea (ECMO) VV y en 1972 por Dr. Robert H. Bartlett ECMO
VA. Es desde allí que se ha ido perfeccionando técnica y equipamiento y
extendiéndose a lo largo del mundo. Varios centros médicos introdujeron este
tipo de tratamiento invasivo para pacientes con SDRA severo, cobrando especial
relevancia durante la pandemia de SARS-CoV-2, o patologías cardiovasculares
críticas como puente a trasplante con éxito.
Nuestra clínica no es ajena a la mencionada
modalidad de soporte vital, siendo en 2018 primer año en utilizarlo. Durante la
curva de aprendizaje con sus éxitos y errores, nos incentivó a un mayor
compromiso y dedicación para mejorar los estándares de atención logrando entre
marzo 2020 y diciembre 2021 la colocación de 9 dispositivos ECMO, 3 VA (33%) y
6 VV (66%), discriminando según sexo femenino 2 (22%) y 7 masculinos (78%). Con
una media de edad 43 años. Presentando en todos los casos como dato relevante
el antecedente de obesidad tipo I y II. La duración promedio de la terapéutica
fue de 10 días. Presentando complicaciones leves como sangrado menor y mayores
como shock séptico, fallo multiorgánico y Óbito.
Teniendo en cuenta nuestra experiencia se
llevaron a cabo cursos de actualización en el manejo y destreza para el
personal en pos de perfeccionar el desarrollo de habilidades.
Nuestro objetivo con esta serie de casos es
comentar nuestra experiencia, dificultades y el aprendizaje durante los años de
pandemia por SARS-CoV-2 con esta modalidad de tratamiento en pacientes con SDRA
severo.


HA Armandola(1), S
Izza(1), EN Diaz Rousseaux(1)
(1) Dr. Jose Maria Cullen.
Introducción: El retiro de la Ventilación Mecánica continúa
siendo un problema importante en las unidades de cuidados intensivos,
incrementa las complicaciones, la morbimortalidad y los costos hospitalarios.
La tasa reportada de falla de extubaciones planeadas es del 2% al 25%.
Objetivo: Conocer la tasa de Fallo de Extubación (FE) y
las características de los pacientes de UTI del Hospital Dr Jose Maria Cullen.
Materiales y Métodos: criterios de inclusión: pacientes ≥18 años
que ingresaron a UTI, entre 1 de Enero y el 31 de Diciembre del 2021, que
requirieron VM invasiva extubados con posibilidad de seguimiento.
Resultados: Se analizaron 109 pacientes. La tasa de FE
fue del 16,51%. Asociaciones significativas: Sexo masculino (0.017), Sin
antecedentes patologicos (<0,001), Politraumatismo (0.044) y Coma (0.049) .
El tiempo de internación tuvo una mediana 20,00 días en el grupo falló
(<0,001) y 5,00 días en el grupo que no. El odd ratio con los días de
internación 1,29-Valor p 0,0000. Asociación estadísticamente significativa
entre mortalidad y fallo de extubación, 8,1 más probable de fallecer (OR: 8,10
valor p: 0,0032).
Conclusiones: En nuestro hospital la tasa de FE fue similar
a lo reportado en la bibliografía, debiéndose esto a más de un factor de
riesgo, el politraumatismo y el com se asociaron a mayor tasa FE.


0052 EVALUACIÓN DE LA
DISFUNCIÓN VENTRICULAR DERECHA EN PACIENTES SÉPTICOS
L Bertorello
Andrade(1), A Sosa(1), A Matarrese(1), F Daldoss(1), G Yossa(1)
(1) Aleman.
Introducción: La miocardiopatía séptica implica una
disfunción orgánica relevante no siempre bien valorada y con impacto en la
morbimortalidad del paciente crítico. Durante mucho tiempo el foco estuvo
puesto en la disfunción ventricular izquierda, y en años recientes el estudio
del corazón derecho ha mostrado también ser un actor fundamental de la
hemodinamia cardiovascular del paciente crítico y del shock séptico en
particular.
En consecuencia nos propusimos evaluar la
prevalencia de disfunción sistólica del ventrículo derecho (DSVD) evaluada por
diferentes métodos y su asociación con la mortalidad
Materiales y método: Se analizó una cohorte prospectiva de
pacientes adultos admitidos a la UCI con diagnóstico de Sepsis desde el 1 de
noviembre de 2021 hasta el 31 de mayo de 2022. La evaluación ecocardiográfica
se realizó dentro de las 24 hs del ingreso, luego de la resucitación inicial.
Para evaluar la función ventricular derecha se utilizó el TAPSE (excursión
sistólica del plano del anillo tricuspídeo), el cambio fraccional del área (CFA
VD) y el strain longitudinal global (SLG.VD). Se analizaron variables clínicas
como edad, sexo, comorbilidades, gravedad al ingreso por APACHE II, días en UCI
y hospital y mortalidad en UCI.
Resultados: Se analizaron un total de 52 pacientes, con
una mortalidad en UCI de 34.6% (n = 18). Las características demográficas se
muestran en la tabla 1. La prevalencia de DSVD mostró diferencias de acuerdo al
método empleado con sus respectivos valores de corte, variando desde un 25%
medido por TAPSE o CFA.VD hasta 87% por SLG.VD (Tabla 2).
Al evaluar mortalidad en pacientes con DSVD,
solo se encontró asociación significativa con la medición por TAPSE (OR 12,7
IC95% 2,5 - 63,7; p= 0,003). Dicha asociación se mantuvo en el modelo
multivariado ajustado por edad y sitio de infección (OR 16,2 IC95% 2,9 - 137;
p= 0,003)..
Conclusión: La prevalencia de disfunción sistólica del VD
fue diferente según el método empleado y considerando los valores de corte de
normalidad reportados, el mejor método para discriminar pacientes con mayor
riesgo de mortalidad en UCI parecería ser el TAPSE.


E Asinari(1), A
Garcia(1), N Buzzi(1), I Bolatti(1), L Pesce Brochero(1), A Furlotti(1), M
Olave Avila(1)
(1) Nuestra Señora De La Misericordia.
Introducción: La infección por COVID19 puede afectar
diferentes aparatos y sistemas. La Necrosis Avascular Ósea (NAV) como
complicación no está bien determinada. El uso de altas dosis de corticoides
podría favorecerla. Trombofilias e hiperfibrinolisis también fueron asociadas
con esta complicación. Afecta la cadera en el 90% de los casos y la rodilla el
10 % restante.
La NAV ha sido reportada en pacientes con
infección por SARSCov1. Pocos casos fueron descriptos luego de infección por
COVID19.
Presentación del caso: Mujer de 51 años con neumonía bilateral por
COVID19. Internación en UTI durante 10 días. Oxigeno suplementario. Recibe
dexametasona, antibióticos y anticoagulación. Evoluciona con intenso dolor en
ambas rodillas que no cede con morfina. Se realiza IRM con importante cambio en
la intensidad de señal a nivel del fémur distal y tibia proximal bilateral,
compatibles con infartos óseos /NAV. Centellograma óseo: intensas anomalías de
captación de ambas rodillas. Se sospecha estado protrombótico asociado. MTHFR y
POLIMORFISMO PAI-1 Heterocigotos. Recibe pamidronato mensual con excelente
evolución, mejoría del dolor, y delimitación del área de infarto óseo.
Discusión: La NAV no ha
sido frecuentemente reportada luego de COVID 19. Existe el riesgo de detectar
un aumento de los casos debido a la hipercoagulabilidad relacionada con la
infección viral, el aumento de la reabsorción ósea y el uso de corticoides.
Esto puede ocurrir hasta un año después de la infección. La pandemia actual
tiene una historia corta y muchas complicaciones no han sido descriptas. Se
sugiere una dosis de 2000 mg de metilprednisolona o equivalente para
desarrollar NAV, pero en infecciones por COVID19 la sensibilidad a
desarrollarla es mayor y puede ocurrir con dosis menores como en nuestro caso,
que recibió 450 mg de equivalente de metilprednisolona. Las mutaciones
trombofílicas encontradas podrían haber jugado un papel potenciador en el
desarrollo de la NAV.
Conclusión: Consideramos este caso de interés por la
afectación bilateral, articulación no típica y haber recibido corticoides en
dosis de bajo riesgo para el desarrollo de NAV, lo que explicaría su etiología
multifactorial.
Debemos tener presente esta complicación
debido a la gran cantidad de pacientes tratados con corticoides por COVID 19,
lo que elevaría su incidencia futura.


0054 EXPERIENCIA DEL USO DE
DUPPLEX TRANSCRANEAL EN UNA UNIDAD DE CUIDADOS CRITICOS INFECTOLOGICA
Y Lamberto(1), P
Saul(1), C Dominguez(1), R Gregori-sabelli(1), N Chacon(1), J Fernandez(1), S
Caceres(1), L Gonzalez(1), P Velazquez Lopez(1), MDLM Nano(1), G Sandez(1), V
Chediack(1), E Cunto(1)
(1) Muñiz.
Introducción: Son bien conocidas las complicaciones
neurológicas de las patologías infecciosas pudiendo cursar con hipertensión
endocraneana, hidrocefalia, complicaciones embolicas, entre otras. El uso de
dupplex transcraneal se ha extendido en las unidades de terapia intensiva, por
resultar un método no invasivo, bed side y con buena sensibilidad para el
monitoreo de pacientes neurocriticos. No existen muchas referencias
bibliográficas de su uso en pacientes neurocriticos infectológicos.
Objetivos: -Describir las alteraciones del patrón de
flujo cerebral mediante dupplex trasncraneal en el paciente infeccioso
neurocritico.
Materiales y método: Se realizo dupplex transcraneal color
codificado modalidad POCUS con traductor sectorial por ventana transtemporal y
occipital en la unidad de terapia intensiva de un hospital monovalente
especialista en Enfermedades Infecciosas de la Ciudad de Buenos Aires a los
pacientes con alteración del sensorio en contexto de patología infecciosa
durante el periodo enero–julio 2022. Se utilizo estadística descriptiva.
Resultados: Se incluyeron 33 pacientes, hombres 70%.
Rango de edad 20 a 78 años, media de 47. 15 pacientes eran VIH positivos. 11
pacientes presentaron tuberculosis meníngea, 3 criptococosis meníngea, 5 lesión
ocupante de espacio, 5 deterioro del sensorio a foco no meníngeo, 4 con
sospecha de paro circulatorio cerebral, 2 síndromes convulsivos, 1 encefalitis,
1 encefalopatía hepática, 1 paciente con antecedentes de ACV y 1 con COVID-19.
25 pacientes presentaron buena ventana
ultrasonografica. En 4 pacientes se objetivo patrón compatible con vasoespasmo
(VM mayor a 120 cm/seg e índice de Lindergar mayor a 3). 2 pacientes
presentaron patrón de hiperemia (VM mayor a 120 cm/seg e índice de Lindergar
menor a 3), 2 signos de hipoflujo con IP mayor a 1.4 y 2 Notch protodiastólico.
2 pacientes presentaron patrón de paro circulatorio cerebral.
Conclusiones: 12 pacientes (36%) presentaron alteraciones
en el patrón del flujo de cerebral. Estas alteraciones guiaron la toma de
decisiones terapéuticas, optimización de PPC, realización de imágenes control,
punciones lumbares control, entre otros. Resulta importante capacitar al
intensivista en esta técnica, dado que es una herramienta útil en el paciente
neurocrítico. Así mismo es interesante estudiar las alteraciones que se pueden
encontrar en los pacientes infecciosos y utilizar los resultados como una
herramienta más para la toma de decisiones.


0055 SAPS III: desempeño en un
servicio de Cuidados Intensivos mixto en Argentina
R Fernandez(1)
(1) Español De Mendoza.
Introducción: En 2005 fue publicado el Simplified Acute
Phisiologic Score III (SAPS III) recopilando datos de una gran muestra de
unidades de cuidados intensivos (UCI) en todo el mundo y utilizando ecuaciones
regionales. Esto facilita la generalización de los resultados. Argentina
participó de la base de datos para el desarrollo del puntaje con 13 UCIs que
aportaron un total de 440 pacientes.
Objetivo: Evaluar el desempeño en cuanto a calibración
y discriminación del SAPS III en una UCI mixta de Argentina.
Material y métodos: Estudio observacional con análisis secundario
de una base de datos prospectiva, (SATI Q), Se tomaron datos registrados en
dicha base para calcular el puntaje SAPS III a partir de una calculadora en
línea de Rapid Critical Care Consult
(https://www.rccc.eu/ppc/indicadores/saps3.html)
Se incluyeron aleatoriamente registros de
pacientes egresados entre 2014 y 2020. Se extrajeron de los registros del SATIQ
datos demográficos y epidemiológicos requeridos para el cálculo del ”score”.
Para cada paciente se obtuvo el puntaje SAPS III, probabilidad de morir
calculada y probabilidad de morir ajustada regional.
Análisis estadístico: Las variables cualitativas se expresan como
frecuencia y porcentajes, con Intervalos de Confianza 95%, (IC
95%), si corresponde. Las cuantitativas se
expresan como mediana y rango intercuartil (RIC).
Se construyeron curvas ROC para la
probabilidad de morir calculada, determinando las AUC, La calibración del
modelo se obtuvo mediante test de Hosmer Lemeshow. Se consideró significativa
estadísticamente p ≤ 0,05.
Resultados: Fueron analizados 1379 pacientes. En la tabla
1 se muestran las características de la población.
El AUC para probabilidad de morir fue 0,847
(IC95% 0,8181 – 0,876), para ecuación general y 0,849 (IC95% 0,820 – 0,878),
para regional.
El test de Hosmer-Lemeshow, mostró un
estadístico C = 18,8; p = 0,016 para el modelo general y de 12,5; p = 0,128
para el modelo regional.
Conclusión: El SAPS III mostró discriminación adecuada
para ambas ecuaciones, similares a las del trabajo original. La calibración fue
mejor para la ecuación regional.
Podría sugerirse un estudio prospectivo
multicéntrico de validación local, con un mayor número de pacientes.


E Arana Osorio(1)
(1) Clinica Cmic.
Introducción: Los pacientes con COVID-19 mostraron una tasa
de mortalidad entre el 30-50%,
en aquellos que presentaron sus formas más
severas de enfermedad y requirieron cuidados intensivos. Esta alta tasa de
mortalidad se asoció al desarrollo de disfunción multiorgánica (DMO) en el
curso de la enfermedad. La DMO podría relacionarse a evolución del SDRA en sus formas
más graves, a lesión directa viral o a sobreinfecciones asociadas.
Objetivos: conocer las variables clínico-epidemiologicas
involucradas y analizar las causas de muerte en nuestra serie de pacientes con
neumonía grave por Sars-Cov 2.
Métodos: Estudio retrospectivo,
observacional, en pacientes ingresados a UTI de la clínica CMIC de Neuquén con
neumonía grave por COVID-19 que requirieron ventilación mecánica entre Abril de
2021 a Enero de 2022
Resultados: Se analizaron un total de 74 pacientes, de
los cuales 56,75% (n=42) fallecieron en la UCI durante el período de estudio.
De los pacientes que fallecieron 88.1% (ver tabla 1) tenían 1 o más
comorbilidades, 59.4%(n=22) hipertensión arterial (HTA), 56.7% obesidad (n=21),
24,3% diabetes mellitus (DM) (n=9), 10.8% enfermedad renal crónica (ERC) (n=4)
entre otras. Encontramos que el shock séptico fue la principal causa de muerte
59% (n=25), seguida del SDRA grave 38% (n=16), TEP 2,3% (n=1), shock
cardiogenico 2,3% (n=1). (Ver figura 1)
Conclusión: Los pacientes con neumonía grave por COVID-19
presentaron en su mayoría como causa principal de muerte Sepsis (59%), seguido
de hipoxemia (38%). Su principal factor de riesgo fue la HTA, aunque la sepsis
como causa de muerte se asocio mas a la obesidad y la DM.


JF Caminos
Eguillor(1), Facultad De Ciencias Médicas, Unlp, G Ferrara(1), Facultad De
Ciencias Médicas, Unlp, MG Buscetti(1),
Facultad De Ciencias Médicas, Unlp, VS
Kanoore Edul(1), Facultad De Ciencias Médicas, Unlp, HS Canales(1), Facultad De
Ciencias Médicas, Unlp, B Lattanzio(1), Facultad De Ciencias Médicas, Unlp, L
Gatti(1), Facultad De Ciencias Médicas,
Unlp, FJ Gutierrez(1), Facultad De Ciencias Médicas, Unlp, A Dubin(1), Facultad De Ciencias
Médicas, Unlp
(1) Farmacología Aplicada Y Terapia
Intensiva. (2) Facultad De Ciencias
Médicas. (3) Unlp.
Introducción: El desarrollo de hipotermia luego del shock
hemorrágico en el trauma es un marcador de gravedad de la injuria y de mal
pronóstico. Sin embargo, los efectos del recalentamiento son controvertidos.
Además, los efectos microcirculatorios del recalentamiento son poco conocidos.
Nuestro objetivo fue estudiar los efectos del aumento de la temperatura central
(T°) sobre diferentes lechos microvasculares. Nuestra hipótesis fue que el
recalentamiento podría deteriorar el flujo microcirculatorio.
Materiales y método: Se estudiaron 24 ovejas de 24 [22-27] kg,
anestesiadas y ventiladas mecánicamente. Se realizaron mediciones de
hemodinamia sistémica, intestinal y renal, consumo de oxígeno (VO
2) y cociente respiratorio (CR) por análisis
de gases espirados, y microcirculación sublingual, mucosa intestinal y
peritubular renal por videomicroscopía. Luego de mediciones basales, se indujo
un sangrado de magnitud suficiente para reducir la presión arterial y el VO
2, y aumentar el cociente respiratorio (CR).
Simultáneamente se redujo la T° hasta 33° C por recirculación gástrica de agua
fría. Después de 1 hora de shock, se retransfundió la sangre extraída. En el
grupo control (n=12) la T° no se modificó, mientras que en el grupo
recalentamiento, se elevó 3° C. Se infundió solución de Ringer lactato para
evitar la hipotensión arterial, hasta un máximo de 40 ml/kg. Las mediciones se
repitieron luego de una hora de reanimación.
Los resultados se analizaron con GEE,
utilizando pruebas de Mann-Whitney y Wilcoxon con ajuste de Bonferroni para
identificar diferencias inter e intragrupo.
Resultados: Los datos más relevantes se muestran en la
tabla 1. Se alcanzaron los objetivos de T°, VO
2, y CR durante el shock. En la resucitación,
el VO
2 permaneció disminuido comparado con el
basal y fue menor en el grupo control. El transporte de oxígeno sistémico
también continuó reducido en ambos grupos. Las alteraciones microcirculatorias
fueron similares en ambos grupos y sólo fueron parcialmente corregidas a nivel
sublingual (Figura 1).
Conclusiones: En el shock hemorrágico, un aumento de la T°
de 3° C no afecta la microcirculación sublingual, intestinal y renal en
comparación con controles hipotérmicos. Durante la reperfusión, el compromiso
microvascular fue mayor en las vellosidades intestinales y la corteza renal que
en la mucosa sublingual.


0059 Intubación por
laringoscopia convencional vs videolaringoscopia en operadores inexpertos
MA Vargas(1), VV
Espíndola(1), LP Marzoratti(1), TC Navarro Toffaletti(1), ÁE Piacenza(1)
(1) Instituto De Cardiología De Corrientes
Juana Francisca Cabral.
Introducción: La intubación traqueal es uno de los
procedimientos más frecuentes en la Unidad de Terapia Intensiva (UTI), que en
el contexto de las residencias médicas tiende a ser realizada por aprendices
sin experiencia, involucrando a pacientes fisiológicamente inestables. En
consecuencia, la intubación exitosa en el primer intento es esencial.
Objetivos: Investigar qué tipo de laringoscopia se
asocia con mayor éxito de intubación en el primer intento en una UTI que
entrena residentes médicos, planteándose la asociación a mayor tasa de éxito a
la intubación traqueal con un videolaringoscopio cuando la realizan operadores
inexpertos.
Material y métodos: Los laringoscopios directos consistían en
dispositivos Macintosh curvos con hoja metálica reutilizable. El
videolaringoscopio consistió en una rama Macintosh curva confeccionado por
impresión 3D FFF con material ABS, con altura de capa de 0.1mm, 100% de
relleno, peso de 180 g, y cámara tipo boroscopio de 5.5 mm de diámetro, 1m de
longitud, IP67 con luz LED, resolución 640x480, conectada a un celular Samsung
J2 Core con tecnología USB OTG. La intubación fue realizada por residentes
médicos de 1º y 2º año, supervisados por un operador experimentado (médico
intensivista o residentes de años superiores). La colocación correcta del tubo
orotraqueal se evaluó mediante auscultación, análisis de las curvas
respiratorias y radiografía de tórax.
Resultados: Se incluyeron 79 pacientes que fueron
intubados en la UTI durante octubre 2021 a junio 2022 que fueron aleatorizados
en dos grupos. El grupo laringoscopio convencional constó en un total de 40
pacientes (50.6%) versus videolaringoscopio 39 pacientes (49.4%). Se intubaron
de forma exitosa en el primer intento 33 pacientes (42%). Con laringoscopio
convencional fueron intubados de manera exitosa en el primer intento 9
pacientes (22.5%); en el grupo videolaringoscopio fueron intubados de manera
exitosa en el primer intento 24 pacientes (61.5%). Se observaron complicaciones
secundarias a la intubación en 39 pacientes (49.4%), perteneciendo al grupo
convencional un 71.8% (28 pacientes), y 28.2% al grupo videolaringoscopio (21
pacientes).
Conclusiones: Se apreció una mayor tasa de éxito en el
primer intento en la intubación y menor tasa de complicaciones con
videolaringoscopia que con laringoscopia directa cuando era realizada por
operadores inexpertos.


0060 NEUMOMEDIASTINO,
NEUMOTÓRAX BILATERAL Y NEUMORRAQUIS EN CRISIS ASMÁTICA SEVERA.
M Latimori(1), F
Garavelli(2), Hospital Escuela Eva Perón, F Dipaolo(2), Hospital Escuela Eva
Perón, M Ramirez Colombres(2), Hospital Escuela Eva Perón, CE Maenza(2),
Hospital Escuela Eva Perón, MD Ré(2),
Hospital Escuela Eva Perón, SP Gattino(2), Hospital Escuela Eva Perón,
NS Rocchetti(2), Hospital Escuela Eva Perón, CJ Settecase(2), Hospital Escuela
Eva Perón, DH Bagilet(2), Hospital Escuela Eva Perón
(1) Hospital Escuela Eva Peron. (2) Servicio
De Terapia Intensiva. (3) Hospital
Escuela Eva Perón.
Introducción: El neumomediastino, neumotórax y neumorraquis
ocurren generalmente como consecuencia de un evento traumático, y son escasos
los reportes en la literatura que hablen de su aparición espontánea y
coexistente. Presentamos el hallazgo de estas tres condiciones en forma
simultánea, como complicación de una crisis asmática.
Caso clínico: Mujer de 27 años, con asma mal controlada,
ingresa a guardia externa por tos seca, dolor precordial de moderada intensidad
y disnea progresiva que no responde a broncodilatadores. Examen físico:
afebril, TA 140/90 mmHg, FR 26 c/min, FC 110 l/min. Sibilancias generalizadas,
sin uso de musculatura accesoria. Radiografía de tórax y ECG: sin alteraciones.
Laboratorio: leucocitos 16500 /mm3, Hb 12,7 g/dl, plaquetas 383000/mm3, VES
10mm/1ra hora., PCR: 3,4 mg/dl, dimero D 0,19 ug/ml, pH 7,46, pO252, pCO230,
bicarbonato 21 mEq/l, EB -1,3, SO2 89,2%, PCR SARS CoV2 negativa.
Se realiza tratamiento médico, sin mejoría.
Se solicita TAC de tórax: neumomediastino, neumotórax laminar bilateral a
predominio derecho, aire en conducto medular, enfisema subcutáneo en pared
torácica. Se coloca untubo de avenamiento pleural derecho e ingresa a Unidad de
Cuidados Intensivos, hemodinámicamente estable, saturando 92% con
oxigenoterapia a 15 l/min, mala mecánica respiratoria. Se decide intubación orotraqueal
y asistencia ventilatoria mecánica (AVM). Intercurre con neumonía asociada a la
AVM con buena respuesta al tratamiento. Se extuba luego de 8 días de AVM y se
traslada a sala general.
Discusión: La incidencia de neumomediastino espontáneo
se estima en un 0,2-0,3 %. Se origina en un aumento de la presión
intraalveolar, rotura alveolar y migración del aire que diseca las vainas
peribronquiales y perivasculares del hilio pulmonar, y se extiende al
mediastino, pudiendo propagarse al tejido subcutáneo, endotorácico, y canal
raquídeo. Los factores precipitantes se relacionan a maniobras de Valsalva,
siendo el asma el factor predisponente más frecuente. Generalmente tiene un
curso benigno, pero la coexistencia de neumotórax se asocia a mayor morbilidad
y riesgo de evolución tórpida.
Conclusión: Creemos importante considerar estos
diagnósticos cuando estamos ante pacientes con crisis asmáticas refractarias,
aun cuando la radiografía de tórax no muestre anomalías, debiendo recurrir a
otros estudios complementarios para documentarlos.
0061 REPORTE DE CASOS:
PIELONEFRITIS ENFISEMATOSA DEL HOSPITAL SIMPLEMENTE EVITA
EM Rodas Montero, G
Izzo(1), M Flores(1), E Solarte(1), L Gonzales(1), A Vera(1), J Angulo(1), A
Rodriguez(1), H Cabrera(1), A Robles(1), C Arellano(1), E Rodriguez(1), E
Velasquez(1), D Choque(1)
(1) Simplemente Evita Gonzalez Catan.
Introducción: Pielonefritis Enfisematosa, infección
necrotizante aguda y grave del riñón, los factores de riegos son: sexo
femenino, Diabetes Mellitus, litiasis renal y uropatía obstructiva. Con
características clínicas: fiebre, dolor en flanco, piuria y taquicardia. Los
organismos frecuentemente E. Coli, Klebsiella pneumoniae, Proteus. Para
diagnóstico se utiliza Tomografía Computarizada. El tratamiento va desde manejo
mínimamente invasivo, hasta Nefrectomía.
CASOS
1°: Diabetico descompensado, secundaria a
ITU, respondiendo con fluidos y antibiótico amplio; realizan TC por alta
sospecha el cual nos da el diagnóstico definitivo de pielonefritis
enfisematosa, realizan drenaje percutáneo con colocación catéter doble J,
llevando a resolución del cuadro.
2°: paciente monorreno, septico, ingresa con
criterios de diálisis de urgencia, administran antibiótico amplio según
filtrado glomerular, no teniendo evolución favorable realizan TC observándose
gas perirenal izquierdo, realizan drenaje percutáneo por ser un paciente
monorreno, evolución favorable llegando a no requerir diálisis posterior.
3°: Diabético descompensado, con factores de
riesgo, realizan TC observando gas en parénquima renal, realizan manejo para
Clase II, no teniendo evolución favorable y presentando factores de mal
pronóstico deciden realizar nefrectomía, obteniendo evolución favorable.
4°: Diabético, reingresa en shock y falla
renal, TC con aire en riñón derecho y dilatación pielocalicial, Ingresa a
quirófano para colocación de catéter doble J, evidencian estenosis ureteral en
unión tercio medio a distal, no pudiendo progresar, terminando procedimiento
sin éxito e inicia hemodiálisis. Reingresando a quirófano para Nefrectomía. Al
día 17 de internación con noradrenalina en ascenso, presenta paro cardiaco, se
realiza maniobras de reanimación, sin éxito, se constata óbito.
Discusión: Presentación clínica con síntomas
inespecíficos que pueden llevar a muerte. Su diagnóstico requiere de tomografía
computarizada, para clasificación y manejo. El tratamiento debe ser
individualizado en cada paciente; iniciar manejo conservador con antibióticos
de amplio espectro, medidas de soporte y según imagen, tomar decisiones terapéuticas
más agresivas que incluyen nefrectomía.
Conclusiones: Emergencia urológica, se presenta en
diabéticos no controlados, sexo femenino, uropatia obstructiva, y anomalía
renal congénita; su diagnóstico debe ser precoz sospechando con los factores de
riesgo y TC para clasificación y manejo temprano para plantear alternativa
terapéutica y disminuir mortalidad.
0062 CAVERNOMA EN TRONCO
ENCEFÁLICO CON HEMORRAGIA RECURRENTE: REPORTE DE CASO
AV Millán(1), CJ
Beroiza(1), M Cruz(1), LG Duran(1), NA Grassi(1), MG Montenegro Fernández(1), M
Petasny(1), NI Zelaya De Leon(1), P Zorzano Osinalde(1)
(1) Hospital Municipal De Agudos Leónidas
Lucero.
Introducción: Las malformaciones vasculares cerebrales
tienen una prevalencia de 0.1 a 4%. De ellas, 0.4-0.7% corresponden a
cavernomas. Suelen ser asintomáticos, excepto en caso de sangrado o efecto de
masa.
Hay pocos informes de manejo no quirúrgico de
cavernomas en tronco encefálico; nuestro objetivo es reportar la evolución
clínica de una paciente con dicha lesión, bajo tratamiento médico y
rehabilitación kinesio-motora.
Presentación del caso: Paciente femenina de 18 años, sin
antecedentes conocidos, que consultó por hemiparesia derecha de 48hs de
evolución.
Se solicitó tomografía de encéfalo, que mostró
imagen hiperdensa heterogénea en protuberancia y mesencéfalo izquierdo que
alcanzaba al tálamo ipsilateral, con edema hasta cápsula interna.
Se interconsultó con Neurocirugía, que
solicitó Angio-resonancia cerebral e internación en UTI.
El estudio informó imagen polilobulada en
mesencéfalo izquierdo, hiperintensa en T1, hipointensa en T2, con edema
perilesional, que comprimía III ventrículo y tálamo homolateral. Se interpretó
como cavernoma.
Mejoró espontáneamente el foco neurológico,
persistiendo con parálisis facial. Neurocirugía descartó conducta quirúrgica
por buena evolución clínica y localización.
Permaneció 11 días internada y se otorgó el
alta con resolución completa de foco.
Reconsulta a las 12hs con clínica de
hipertensión endocraneana y requerimiento de intubación orotraqueal por mala
mecánica ventilatoria. En tomografía control, se evidencia resangrado. Se
descartó conducta quirúrgica por parte de centro de mayor complejidad.
Tras 16 días en UTI, pasa a sala general y se
externa a los 60 días, persistiendo con parálisis facial derecha.
Discusión: Los cavernomas son un subtipo de angioma
caracterizados por presentar una estructura trabeculada con espacios vasculares
con un flujo sanguíneo lento, que genera estasis y trombosis. El riesgo de hemorragia
está relacionado principalmente con la localización, siendo el tronco
encefálico la de mayor riesgo. Sin embargo, en el caso relatado, se consideró
que los riesgos del abordaje quirúrgico eran inaceptables, por lo que se
realizó tratamiento de sostén y rehabilitación kinesio-motora, logrando mejoría
de síntomas neurológicos.
Conclusión: Si bien el único tratamiento que permite
controlar definitivamente los cavernomas, es la resección quirúrgica, ésta se
encuentra raramente disponible para aquellos de localización infratentorial.
Sin embargo, el trabajo multidisciplinario
entre intensivistas, neurocirujanos, kinesiólogos, permite el sostén del
paciente y la mejoría de su focalidad neurológica.


0063 ENCEFALITIS AUTOINMUNE
COMO CAUSA DE ESTATUS EPILEPTICO NO CONVULSIVO: REPORTE DE CASO
J Voss(1), JI
Moreno(1), R Segovia(1), N Muicela(1), A Ayarde(1), N Tanel(1), D Ullunque(1),
L Rocha(1), F Freile(1), A Aliaga(1), G Jacob(1), L Alejandra(1), M Nahra(1)
(1) Español.
Introducción: La encefalitis autoinmune (EA) comprende un
grupo de trastornos inflamatorios del parénquima cerebral no infecciosos
mediados por el sistema inmunitario. Dentro de las causas de meningoencefalitis
es la segunda en frecuencia (21%) luego de las infecciones. La encefalomielitis
aguda diseminada es la causa autoinmune más frecuente, seguida por la causada
por anticuerpos anti R-NMDA.
Presentación del caso: Paciente femenina de 77 años con antecedente
de cáncer de mama con tratamiento quirúrgico y quimioterapia hace 3 años,
actualmente medicada con tamoxifeno.
Ingresa por deterioro sensorio GCS 11/15
(M5O3V3) e hipotonía generalizada y simétrica (escala Daniels 3 ⁄ 5) de una
semana de evolución. Presenta tomografía de encéfalo sin alteración aguda, LCR
no patológico con muestras para neurovirus negativas y electroencefalograma que
evidencia ondas epileptiformes por lo que se trata con levetiracetam.
Evoluciona con deterioro del sensorio: GCS 8/15 (M5O2V1), se realiza intubación
orotraqueal. Por sospecha de status no convulsivo se inicia sedación con
midazolam, electroencefalograma control sin descargas. Intercurre con
hemorragia digestiva baja con hallazgo de tumor colónico. Se interpreta como
probable EA por lo que se realiza tratamiento con metilprednisolona con mejoría
franca del sensorio. Intercurre con shock séptico y muerte. Se recibe
postmortem reporte de proteinograma electroforético confirmando encefalitis
(AMPA y NMDA-C positivos).
Discusión: Las EA deben considerarse entre los
diagnósticos diferenciales de los estatus epilépticos sin causas evidentes. Es
una patología subdiagnosticada en las unidades de terapia intensiva, aunque se
observa un aumento del reporte de casos en los últimos 10 años, asociado al
avance en la detección de anticuerpos.
Las EA, al tener una causa predominantemente
de tipo humoral, presentan buena evolución con el tratamiento inmunosupresor:
corticoides, inmunoglobulinas, plasmaféresis o anticuerpos monoclonales, por lo
que son importantes el diagnóstico y tratamiento precoces.
Conclusiones: El estudio de causas poco frecuentes de
estatus epileptico no convulsivo es complejo por el alto costo y difícil acceso
a los estudios específicos, pero consideramos que dado el aumento de la
incidencia de EA en especial en pacientes gerontes y oncológicos, es una
patología que debe ser considerada y estudiada.

0064 Encefalopatía espongiforme
transmisible humana: reporte de un caso
J Voss(1), A
Aliaga(1), R Segovia(1), J Moreno(1), F Freile(1), L Rocha(1), N Muicela(1), N
Tanel(1), D Ullunque(1), A Ayarde(1), J Guillermina(1), A Luquetti(1), A
Orozco(1), N Melina(1)
(1) Español.
Introducción: Las prionopatías son patologías
neurodegenerativas, consecuencia de acúmulos de una iso-forma anormal de la proteína
priónica celular (PrPc),. La acumulación residual de priones, produce una
alteración de la homeostasis neuronal propiciando el desarrollo de la
encefalopatía espongiforme mortal de la Enfermedad de Creutzfeldt-Jakob (ECJ).
Esta enfermedad es transmisible tanto en humanos como en animales.
Resumen: Masculino de 82 años, con antecedentes de
HTA, por desorientación temporo-espacial, asociado a trastornos en la marcha y
miocolonias. RMN de encéfalo que informa proceso infeccioso/inflamatorio
temporal bilateral compatible con encefalitis. AngioRMN que informa vacío de
flujo conservado.
Se interna con diagnóstico de encefalitis en
estudio, realizándose laboratorios específicos en sangre y LCR para las
diferentes encefalitis siendo negativos. EEG sin grafoelementos epileptiformes,
ni signos de encefalopatía inflamatoria/infecciosa.
Por mala evolución neurológica se interpreta
cuadro como probable encefalopatía autoinmune vs paraneoplásica, se realizan
pulsos de metilprednisolona por 4 días sin cambios del cuadro clínico,
evolucionando a status epiléptico e ingresando a UTI, por lenta evolución en su
aspecto neurológico requiere TQT y se realiza nueva punción lumbar para toma de
muestra de LCR para biología molecular de proteína 14.3.3 por sospecha elevada de
encefalopatía espongiforme falleciendo antes de recibir el resultado de
proteína 14.3.3 positivo para encefalopatía espongiforme, confirmando sospecha
diagnóstica
Conclusión: Presentamos el caso como causa poco frecuente
de encefalitis, siendo importante como diagnóstico diferencial entre las
etiologías virales y autoinmunes, la bibliografía revisada reporta un elevado
subdiagnóstico de esta enfermedad, que puede ser por su elevada complejidad
diagnóstica requiriendo exámenes específicos ( Proteína 14-3-3, EEG etc.) o por
su bajo índice de sospecha, quedando enmascarada entre las encefalitis
idiopáticas.
Otro aspecto importante de la enfermedad es
la ausencia de tratamiento y su posible transmisión hereditaria lo cual nos
obliga agotar todos los medios para llegar al diagnóstico.


0065 SHOCK ANAFILACTICO
CONFIRMADO POR MEDICION DE TRIPTASA SERICA SERIADA
A Gira(1), M
Cardonati(1), F Leveratto(1), J Alvarez(1), P Pratesi(1)
(1) Universitario Austral.
Introducción: En la Anafilaxia, el segundo contacto del
Antígeno a las Ig E de mastocitos liberan: Histamina, Prostaglandinas,
Leucotrienos y proteasas como la Triptasa en la fase aguda que dura minutos.
La triptasa posee Sensibilidad 73% y
Especificidad 98%, Valor normal 3,8 a 11,4 ug/L, pueden haber valores elevados
en Leucemia, IRC, Falla hepática crónica.
Otras determinaciones de laboratorio:
Histamina, PAF, Quimasa, Basogranulina, ensayo de mutacion KIT.
Presentación del caso: Mujer de 47 años, colecistecomia
laparoscópica 14 dias previo a ingreso a clínica por sepsis a foco biliar, se
realiza TC de abdomen con contraste EV constata lesión de vía biliar, en
segunda TC tras contraste EV presenta: disnea, Glasgow 3/15, FC 140 lat./m, TA
40/20 mmHg, Sat 68%, rash, convulsiones, midriasis, se administra Adrenalina,
ingresa a UCI, se toman muestras para triptasa a los 25 minutos (3, 7 ug/L), a
las 2 hs (74,8 ug/L) y a las 20 hs (14,6 ug/L).
Se realiza hepaticoyeyunoanastomosis y a los
14 dias pasa a clínica medica.
Discusión: La cinética de Triptasa comprende: injuria,
pico 75 min, meseta 2 hs, caída 12 hs, valor basal 24 hs Se estandariza tres
tomas de muestras séricas: inmediata, 90 -120 minutos y 24 hs. En nuestro caso
pudimos relacionar la curva de tripas con Anafilaxia y descartar shock séptico.
La curva puede seguir 3 caminos: niveles
altos y luego bajan en Anafilaxia, valores siempre altos Mastocitosis sistémica
y valores siempre bajos Mastocitosis de piel.
Conclusión: Realizar la curva de triptasa para el
diagnóstico definitivo para diferenciarlo de otras patologías
Z Carlos Matías
Ezequiel(1), ML Braccini(1), DE Miño(1), TC Navarro Toffaletti(1), P
Piacenza(1)
(1) Instituto De Cardiología De Corrientes
Juana Francisca Cabral.
Introducción: La terapia de oxígeno de alto flujo
administrada mediante cánulas nasales (CNAF) mejora la oxigenación y disminuye
el trabajo respiratorio en pacientes críticos. Los efectos fisiológicos
aplicados en pacientes traqueostomizados con weaning dificultoso como paso
previo a la ventilación espontánea son poco conocidos. Utilizamos OTAF en una
paciente con la hipótesis que el método reduciría el esfuerzo inspiratorio,
mejoraría el patrón ventilatorio y optimizaría el confort, favoreciéndose así
la desvinculación de la AMVP.
Presentación del caso: Paciente de 49 años, portadora de estenosis
aortica, miocardiopatía dilatada, hipertensión pulmonar, insuficiencia cardiaca
crónica con marcapasos definitivo. El 21/4/22 es admitida debido a
insuficiencia cardiaca descompensada. El 12/05/22 se realiza reemplazo valvular
aórtico con prótesis mecánica. Presenta múltiples complicaciones: bajo gasto
cardíaco, neumonía asociada a los cuidados de la salud, mediastinitis,
hidroneumotorax que requirió de videotoracoscopia y AMV prolongado (57 días).
Traqueostomía quirúrgica desde el día 02/06/22.
El 07/07/2022 se inicia weaning en modo
Presión Soporte y desconexiones periódicas con T/T no lográndose una adecuada
progresión. El 19/07/22 se comienza a utilizar OTAF, adaptando la cánula de
traqueostomía con conector con whisper. Se utilizó el AirVo2 con FIO2 21%,
flujo 35 l/min, temperatura 36ºC. La paciente presentó buena tolerancia y
confort. Este método fue utilizado por periodos de duración creciente durante 2
semanas. El 26/7/22 se logra desvinculación definitiva de la AMV y
posteriormente decanulación exitosa. Alta el 04/08/22.
Discusión: El weaning dificultoso en pacientes con AMVP
y Traqueostomía resulta desafiante para cualquier servicio de cuidados
intensivos, pudiendo requerir durante el proceso estrategias no convencionales
de soporte respiratorio. El uso de la OTAF es una opción válida poco utilizada.
Conclusión: El empleo de la OTAF como soporte
respiratorio en pacientes traqueostomizados con AMVP, puede ser considerado un
método alternativo y eficaz en el proceso de weaning. Los efectos fisiológicos
ya conocidos por la aplicación de CNAF, pueden extrapolarse a este tipo de
pacientes utilizando la técnica correcta de aplicación.


F Guzmán Tapia(1),
JC Uribe Caballero(1), S Castro(1), ML Salazar Hernandez(1), A Fray(1), M
Flores, M Morante(1)
(1) Higa Eva Peron San Martin.
Introducción: las complicaciones relacionadas con la
traqueotomía perioperatoria se describen en un 2-6 % de los casos y las post-operatorias
entre un 9-17%.. La traqueotomía percutánea se comenzó a implementar en nuestra
terapia en el año 2001.
Objetivo: analizar la frecuencia y tipo de
complicaciones relacionadas a dicho procedimiento y la mortalidad dentro de la
terapia intensiva.
Material y método: estudio descriptivo y
retrospectivo. Se incluyeron pacientes ingresados entre enero de 2021 y mayo de
2022. Se consignaron las complicaciones del procedimiento quirúrgico o
percutáneo. La mortalidad global en la Terapia.
Resultados: sobre un total de 84 procedimientos, se
realizaron 36 traqueotomías quirúrgicas y 48 percutáneas. En el grupo de
traqueotomía percutánea se observo mayor proporción de pacientes de sexo
masculino (73 %) e hipertensos, así como predominio de motivos neurológicos/neuroquirurgicos
de ingreso a la Unidad. Las complicaciones de ambos procedimientos fueron entre
otras las siguientes: infección de sitio quirúrgico (10), sangrado local (7),
desplazamiento de la cánula (8), estenosis de la vía aérea (3), granuloma de
cuerda vocal (1); ningún fallecido durante el procedimiento. La mortalidad
global en terapia fue 35/84 (41.6%) y en este grupo los pacientes eran más
añosos, obesos y requirieron mayor abordaje quirúrgico con respecto a los que
sobrevivieron.
Conclusiones: En nuestra población, comparando la
traqueotomía percutánea con la quirúrgica, no hay diferencias significativas en
cuanto a la edad o los días de traqueotomía; si se evidencia menor mortalidad
en el primer grupo. La infección de sitio quirúrgico fue la complicación más
importante de ambas técnicas. En cuanto a los fallecidos, probablemente la
elevada mortalidad se vea vinculada a la gravedad de la patología de base e
intercurrencias agregadas durante su estancia en la Unidad.

0070 Manejo multidisciplinario
en gran quemada embarazada
A Regules
Armiñana(1), E Ghisolfi(1), JM Pina(1), R Paffumi(1), A Chena(1), M
Chocobar(1), L Fernandez(1)
(1) Luis Lagomaggiore.
Introducción: Las quemaduras extensas y el lugar de estas
generan gran morbilidad y mortalidad asociada a las lesiones mismas y a la
calidad de la reanimacion inicial. Debido a los cambios fisiologicos del
embarazo, en una paciente gran quemada, se presenta el desafio de una
reanimacion mas controlada con metas ajustadas a la condicion de la paciente.
Descripción: Paciente 39 años sin antecedentes, cursando
embarazo de 25 semanas, que presenta, en intento de autolisis, quemaduras del
30% de la superficie corporal de tipo AB/B, en torax, abdomen, rostro, cuello y
miembros superiores. Derivada de nosocomio de la provincia de Neuquen donde
recibio atencion inicial las primeras 48 horas. Al ingreso se conecta a
asistencia respiratoria mecanica, se realiza via venosa central, par
gasometrico, control de temperatura central y periferica, cateter arterial en
piel sana, monitoreo multiparametrico y plataforma de monitoreo hemodinamico
minimamente invasivo (EV 1000), analitica de control, limpieza quirurgica de
quemaduras, momitoreo fetal y maduracion pulmonar fetal completa, vacuna y gammaglobulina
antitetanica, manta termica y toma de cultivos.
Evolución: Se realiza fluidoterapia guiada por
dispositivos minimamente invasivos y ultrasonografia. Antibioticoterapia
dirigida, bacteriemia por SAMS y candida no albicans. Terapia transfusional
postquirurgica guiada por Rotem. Ventilacion mecanica protectiva y
desvinculacion de la misma 10 dias posteriores al ingreso. (CUADRO 1). Por
monitoreo fetal diario se detecta ecografia fetal doppler patologica por lo que
se realiza cesarea con feto vivo de 27,4 semanas.
Conclusión: Podemos determinar que el abordaje
multidisciplinario, la reanimacion con fluidos dirigidas por medio de
dispositivos minimamente invasivos y ultrasonografia a las necesidades
temporales de la paciente combinados con una intervencion quirurgica temprana
nos permiten disminuir las complicaciones de una fluidoterapia excesiva,
aumentando el exito de las intervenciones quirurgicas, disminuyendo los dias de
ventilacion mecanica, generando menor morbi-mortalidad. A considerar en estas
pacientes la intoxicacion por monoxido de carbono, ya que este gas atraviesa
libremente la placenta.

![]()
D Villalba(2), E
Navarro(1), A Matesa(2), A Brusco(3), V Morales(3), GG Morel Vulliez(1), E
Rositi(1), L Prieto(4), M Bosso(4), S De Paoli(5), A Cotero(5), J Nadur(5), M Santini(6),
M Alonso(6), F Larroca(4), C Duarte(7), V Garcia(7), R Campodónico(7), G
Musso(8), M Leingruber(8), A Morales(9), A Segura(10), ME Vallory(10), S
Pieruzzi(11), P Pascal(11), EL De Vito(1)
(1) Centro Del Parque. (2) Clínica Basilea.
(3) Alcla. (4) Santa Catalina - Neurorehabilitación Clínica. (5) Ciarec. (6)
Clínica Pasteur. (7) Ulme. (8) Aprepa. (9) Centro Médico Amenabar. (10) Caice.
(11) Clínica Semed.
Introducción: Los datos epidemiológicos y clínicos de
pacientes con COVID-19 que sobrevivieron al evento agudo y fueron derivados a
centros de desvinculación de la ventilación mecánica y rehabilitación (CDVMR)
son escasos, particularmente en países de ingresos bajos y medios. Nuestro
objetivo fue describir las características clínicas, la epidemiología y los
resultados de los pacientes con enfermedad por COVID-19 traqueostomizados en
Argentina que fueron dados de alta de la unidad de cuidados intensivos (UCI) e
ingresados en los CDVMR.
Métodos: Estudio prospectivo, multicéntrico,
observacional (Consorcio Grupo Re.Des.) desarrollado entre julio de 2020 y
diciembre de 2021, en 12 CDVMR de Argentina. Se registraron características
demográficas, datos de laboratorio, función pulmonar y dependencia de
ventilación mecánica (VM) al ingreso a los CDVMR. También se registraron
desvinculación de la VM, decanulación y el estado al alta. Se construyó un
modelo de regresión logística múltiple para predecir el alta domiciliaria.
Resultados: Inscribimos a 568 pacientes adultos
traqueostomizados luego de la fase aguda de COVID-19 transferidos a los CDVMR
participantes del estudio. La mediana de estadía en la UCI fue de 42 días; la
mediana de edad fue de 62 años, el 70,0% eran hombres y la mediana del índice
de comorbilidad de Charlson (ICC) fue de 2. De los 315 pacientes ingresados con ventilación mecánica, se logró la
desvinculación en 228 pacientes (72,4%) y se decanularon 427 (75,2%). La
mediana de estadía en los CDVMR fue de 60 días; 366 pacientes (64,5%) fueron
dados de alta a domicilio y la tasa de mortalidad fue del 6,0%. En el análisis
multivariado, la edad, el ICC, la duración de la VM en la UCI, la insuficiencia
renal y la debilidad de los músculos espiratorios se asociaron de forma
independiente con el alta domiciliaria.
Conclusiones: La mayoría de los pacientes con COVID-19
transferidos de las UCI a los CDVMR se desvincularon con éxito de la VM,
lograron la decanulación y el alta domiciliaria. Nuestros datos podrían ayudar
a identificar áreas de mejora en el manejo de pacientes en países de bajos y medianos
ingresos y en otros países.
A Potenzoni(1), Y
Benavente(1)
(1) Hospital Italiano.
Introducción: La vacación de sedación diaria (VSD)
involucra el cese de la medicación sedante con el fin de poder determinar la
mínima dosis requerida por el paciente e identificar oportunidades para la
extubación o progresión en el weaning.
Actualmente, la Unidad de Terapia Intensiva
de Adultos (UTIA) de un Hospital de alta complejidad en Buenos Aires, cuenta
con un protocolo de VSD el cual involucra enfermeros, médicos y kinesiólogos.
Durante la pandemia por el Covid-19,debido a
la situación epidemiológica, la aplicación de la VSD se vió obstaculizada.
Por este motivo, volvimos a medir la
interrupción de la VSD para observar el cumplimiento, comparándolos con los
datos del año 2019.
Objetivo primario
Evaluar el cumplimiento de la interrupción de
VSD por parte del plantel de enfermería entre los meses de Marzo - Abril 2022
frente a los meses Marzo - Abril 2019 en una unidad de terapia intensiva de
adultos de un Hospital de alta complejidad en Buenos Aires.
Objetivos secundarios
Analizar el resultado de la VSD diaria de la
UTIA en el periodo Marzo - Abril 2022.
Materiales y método: Estudio observacional, descriptivo,
transversal. Se recabaron datos de la Historia Clínica Electrónica (HCE) y
mediante observación directa, sin intervención. Entre los meses de Marzo 2022 -
Abril 2022. Los datos obtenidos se compararon con los recabados en los meses de
Marzo - Abril 2019.
Resultados: Se realizaron 277 observaciones. El 55%
estaban contraindicadas y el 45% estaban en condiciones de realizar la VSD.
En el 62% de las observaciones se realizaron
la VSD de forma correcta y en el 38% no.
Conclusión: A pesar de que durante la pandemia se produjo
una disminución de la VSD, al comparar el periodo Marzo - Abril 2019 contra
Marzo - Abril 2022 se observa un aumento significativo del cumplimiento de la
interrupción de la VSD, dando al personal de enfermería la autonomía que tienen
en la realización de VSD.


A Vicente(1), D
Villalba(2), L Diaz Ballvé(3), P Pedace(2), E Perez Calvo(2), P Tocalini(2), JM
Carballo(2), K Torres(2), G Petraroia(2), J Collins(2), A Matesa(2), G Gil
Rossetti(2), N Golfarini(2), P Pini(2), L áreas(2), A Del Valle(2), M
Scrigna(2), E Distefano(2), F Planells(2)
(1) Basilea. (2) Clínica Basilea. (3)
Hospital Posadas.
Introducción: En Argentina, el 24,3% de los pacientes
adultos con diagnóstico de COVID-19 requirieron la realización de una
traqueostomía para facilitar el proceso de desvinculación de la ventilación
mecánica. Durante la pandemia aumentó el número de pacientes con intubación
prolongada y traqueostomía tardías, lo cual podría predisponer al aumento de
lesiones laringotraqueales. Sin embargo, hasta el momento se desconocen
estudios que evalúen dicha hipótesis.
Objetivo: evaluar si los pacientes adultos
traqueostomizados post-COVID-19 tuvieron mayor prevalencia de lesiones
laringotraqueales en comparación con un control histórico sin COVID-19.
Materiales y método: se realizó un estudio analítico,
observacional y transversal en un centro de desvinculación de la ventilación
mecánica y rehabilitación. Se incluyeron pacientes adultos con traqueostomía y
que se les haya realizado una fibrobroncoscopía al ingreso a la institución. Se
realizó un análisis por puntaje de propensión donde se seleccionaron mediante
un emparejamiento 1:1 los pacientes post-COVID-19 versus un control histórico
de pacientes sin COVID-19. El análisis se emparejó por edad, días de intubación
orotraqueal previo a la realización de la traqueostomía, días de vía aérea
artificial hasta la realización de la fibrobroncoscopía y días de ventilación
mecánica en la unidad de cuidados intensivos.
Resultados: ingresaron al estudio 50 pacientes
traqueostomizados post-COVID-19, de los cuales uno debió eliminarse del
análisis por imposibilidad de realizar un emparejamiento adecuado. Se
analizaron finalmente 49 pacientes en cada grupo. La prevalencia de lesiones en
la vía aérea en pacientes post-COVID-19 versus un control histórico sin
COVID-19 fue del 53,1% y del 73,5%, respectivamente (p= 0.059). En el grupo
post-COVID-19, el 23,1% presentaron lesiones severas y en el control histórico
sin COVID-19 el 27,8%. La lesión más frecuente en ambos grupos fue el
granuloma, mientras que el sitio predominante de presencia de lesión fue a
nivel subglótico.
Conclusiones: no se hallaron diferencias en la prevalencia
de lesiones de vía aérea en pacientes traqueostomizados post-COVID-19 en
comparación con un control histórico emparejado sin dicha condición.
JC Uribe
Caballero(1), F Guzman(1), S Castro(1), ML Salazar Hernandez(1), A Fray(1), M
Flores, M Morante(1)
(1) Higa Eva Peron San Martin.
Introducción: La traqueotomía es un procedimiento indicado
en terapia intensiva, que permite la protección y acceso a la vía aérea
disminuyendo las lesiones traqueales asociadas a la intubación prolongada. En
nuestro servicio el procedimiento quirúrgico es realizado por cirujanos y la
técnica percutánea por los terapistas.
Objetivo: analizar que patología de base es la que más
requiere este procedimiento y a cuanto tiempo de la intubación se realiza el
mismo.
Material y método: estudio descriptivo y retrospectivo. Se
analizaron pacientes entre enero de 2021 y mayo de 2022. Se tomo en cuenta la
edad, sexo, motivo de ingreso, comorbilidades principales, procedimiento
quirúrgico o percutáneo, tiempo de intubación endotraqueal entre otros.
Mortalidad global.
Resultados: se incluyeron en el análisis 84 pacientes en
total. La mediana de edad fue de 57 años y de internación 33 días en el periodo
de estudio. Las comorbilidades más
frecuentemente encontradas: HTA en primer
lugar; seguido por DBT y obesidad en igual número. Los motivos de ingreso
principales fueron la causa neurológica/neuroquirurgica (53.5%) , seguida por
neumonía por covid, de la comunidad e intrahospitalaria (26.1%).Traqueotomía
realizada en primera semana (1-7) : 3 pacientes, 2º semana (8-14) : 22
pacientes, 3º semana (15-21) : 40 pacientes, 4º semana (22-28) : 15 pacientes,
5º semana ( 29- 35) : 4 pacientes.
Conclusiones: en nuestra población, predomino el sexo
masculino y el paciente neurológico o neuroquirurgico fue más frecuentemente
sometido al procedimiento, debido a bajo score neurológico y/o mal manejo de
secreciones. La técnica percutánea fue la más empleada en nuestro Servicio. La
mayoría de las traqueotomías fueron tardías.

G Vecchio(1), J
Sanchez(1)
(1) Hospital Italiano De Buenos Aires.
Introducción: La mayoría de los pacientes internados en la
Unidad de Cuidados Intensivos (UCI) reciben fármacos por vía endovenosa (VE).
Existen criterios del paciente y del medicamento que permiten definir el
momento oportuno para rotar a vía oral o enteral (VO). En muchos casos, aunque
ya se pueda realizar el cambio, se mantiene la prescripción endovenosa
aumentando los riesgos para el paciente (infecciones asociadas a catéter,
efectos adversos, etc) y costos de internación (presentación inyectable,
trabajo de enfermería, insumos descartables.)
Objetivos: Cuantificar el impacto en costos y
efectividad del cambio de indicaciones endovenosas a VO sugeridas por un
farmacéutico clínico en la UCI.
Materiales y métodos: Estudio retrospectivo observacional. Se
relevaron las intervenciones farmacéuticas realizadas en el mes de enero del
año 2022, en los pacientes de la UCI de un hospital privado, en las que se
sugería cambio de VE a VO. Se calculó la disminución en los costos de aquellas
que fueron aceptadas: diferencia de precio para igual dosis de medicación en 24
horas entre la presentación endovenosa y la presentación oral.
Se verificó si luego de pasar paracetamol
endovenoso a vía oral los pacientes requirieron rescates para controlar el
dolor.
Resultados: Durante el mes de enero de 2022 se realizaron
46 intervenciones farmacéuticas sugiriendo pasaje de VE a VO, de las cuales se
aceptaron 31, generando una reducción del 98 % (38770.64 $AR) en los costos
directos de las indicaciones analizadas.
El medicamento con mayor impacto económico es
el paracetamol, pero el 16.1% de las intervenciones hechas sobre este fármaco
no fueron aceptadas sin criterios que contraindiquen la vía oral.
De los 20 pacientes con indicación endovenosa
de paracetamol que fueron rotados a vía oral, solo 1 requirió rescates para
controlar el dolor: el 95% de los pacientes presentó igual efectividad
analgésica al cambiar la vía de administración.
Conclusiones: El pasaje a vía oral o enteral en el momento
apropiado en pacientes críticos genera una disminución significativa en los
costos de medicamentos.
Para el paracetamol el cambio en la vía de
administración no representa una disminución en el efecto analgésico.
La intervención del farmacéutico contribuye a
implementar estos cambios.


0076 Botulismo del lactante:
Estudio descriptivo en una Unidad de Cuidados Intensivos Pediátricos
C Avila(1), G
Kaltenbach(1), MM Cardenas(1)
(1) Hospital Provincial Neuquén.
Introducción: El botulismo del lactante (BL) es la forma
más frecuente de botulismo humano en Argentina. El objetivo es describir
aspectos esenciales del diagnóstico y manejo durante la internación de
pacientes con BL internados en el Servicio de Terapia Intensiva Pediátrica
(STIP).
Métodos: Estudio observacional, descriptivo y
retrospectivo. Se utilizó la base de datos del STIP con diagnóstico de BL en el
periodo 2005-2020. Se registraron variables demográficas, métodos de
diagnóstico, días de asistencia respiratoria mecánica convencional (ARMc), de
ventilación no invasiva (VNI), estadía en STIP, mortalidad al alta
hospitalaria.
Resultados: Se registraron 21 pacientes con BL, 66.7 %
fueron varones, con una mediana de edad de 5 meses (RIC 2-6 m). El diagnóstico
fue mediante técnica de bioensayo, detectándose toxina en suero en 57.1 %. Uno
solo no requirió ARMc, un paciente fue traqueotomizado, el 85 % recibieron ATB,
24 % recibieron VNI. Ningún paciente recibió antitoxina y no hubo fallecidos.
La mediana de estadía hospitalaria fue 66 días (RI: 42-76); de internación en
STIP 48 días (RI: 29-78); y de ARMc 37 días (RI: 26-64). La demora en la
confirmación diagnóstica fue 15.8 +/- 4.8 días.
Conclusiones: La totalidad de los pacientes fueron
diagnosticados con la técnica de bioensayo, que genera un tiempo de demora
diagnóstica que exceden los lapsos recomendados para la administración del
tratamiento específico. Ningún paciente recibió tratamiento específico. El BL
presentó baja mortalidad, pero tiempos de ARM e internación prolongados, que se
asocian a uso frecuente de antibióticos.
0077 REPORTE DE CASO: BOTULISMO
ALIMENTARIO CON PERFORACIÓN INTESTINAL EN UNA ADOLESCENTE
SI Ramos
Elizagaray(1), ML Piovano(1)
(1) Notti.
Introducción: El botulismo alimentario es una intoxicación
paralizante poco frecuente, adquirida por la ingesta de neurotoxinas producidas
por C. botulinum. En Mendoza se reportó 1 caso en los últimos 4 años, no
existiendo reportes en menores de 18 años desde el 2015. A nivel nacional, se
reportan alrededor de 1 caso/año desde el 2015.
Presentación de caso: Una adolescente de 13 años consultó por
vómitos incoercibles y deposiciones líquidas con sangre 12 horas después de
ingerir una conserva casera. Fue internada con clínica de abdomen agudo,
evolucionando las siguientes 24 hs con ptosis palpebral, diplopía, disfonía y
dificultad respiratoria. Ingresó a terapia intensiva con sospecha de botulismo
alimentario a las 32 horas de la ingesta, donde se administró antitoxina
botulínica equina y permaneció 35 días en soporte ventilatorio, requiriendo
traqueostomía a los 27 días de internación. Presentó además íleo paralítico
desde su ingreso, con requerimientos de nutrición parenteral y múltiples
perforaciones en yeyuno e íleon por las que requirió 3 intervenciones
quirúrgicas. Paralelamente asoció depresión y rechazo al tratamiento, por la
que fue abordada por salud mental y medicada con antidepresivos. Egresó con
requerimientos de soporte ventilatorio y nutrición por sonda transpilórica a
los 72 días de internación.
Discusión: El botulismo es una enfermedad de difícil
diagnóstico en pediatría, frecuentemente confundida con patologías
neuroparalizantes más frecuentes como el síndrome de Guillain-Barre, miastenia
e infecciones del sistema nervioso central, entre otras. El diagnóstico de certeza
depende de la inoculación de muestras de suero o materia fecal del paciente en
ratones y puede tardar más de 48 horas. Existen otras técnicas por PCR
cuantitativa y microgota con capacidad de detectar toxinas A y B en plasma con
una sensibilidad del 100% hasta 0.84 copias/μl, las cuales no están disponibles
en nuestro país.
Conclusión: Actualmente el diagnóstico del botulismo
alimentario en pediatría depende de la alta sospecha clínica, y en la mayoría
de los casos el tratamiento con inmunoglobulinas específicas se administra
empíricamente por las dificultades en la confirmación a través del bioensayo.
La asociación con comorbilidad psiquiátrica y gastrointestinal está descripta
en poblaciones adultas. El abordaje interdisciplinario precoz resulta relevante
en niños.
L Solis(1), JE
Alfonso(1), L Ojeda Flores(1), K Velazquez(1), LB Costa(1), C Pisarello(1), Y
Lesieux(1), MV Ivan(1), C Mizdraji(1), L Huespe(1), S Lazzeri(1), H Alvarez(1),
JC Garcia Roth(1)
(1) Hospital Escuela Gral. San Martin.
Introducción: Las
manifestaciones neurologicas del Linfoma de celulas B son raras en pacientes
inmunocompetentes. En tales casos, estas lesiones pueden simular hemorragias o
tumores intracraneales.
Presentación del caso: Masculino de 60 años, ex tabaquista. Se presenta con dolor lumbar y
cefalea de dos semanas de evolución recibiendo tratamiento sintomático con
analgésicos. Se realiza RNM de cerebro sin hallazgos significativos. El
28/06/2022 evoluciona con trastorno del sensorio (GSC 5/15) ingresando al
servicio de emergencias. Se realiza TC de Cerebro que evidencia hematoma
subdural agudo con desplazamiento de línea media e imagen nodular densidad
partes blandas de 16mm en orbita derecha. Laboratorio: Hb 12.8, GB 29.650,
Plaquetas 24.000. El 29/06/2022 se certifica la muerte encefálica por Duplex
Transcraneal. Ecografía abdominal evidencia parénquima hepático heterogéneo con
múltiples imágenes redondeadas hipoecogénicas y esplenomegalia. En frotis
sanguíneo se observan blastos linfoides vacuolados. Se solicita citometría de
flujo que informa Linfoma de estirpe linfoide B. CMV (IGM /IGG) y EPSTEIN BARR
(IGM /IGG) no reactivo. Estudio Citogenético de sangre periférica que informa
cariotipo normal 46,XY [20].
Discusión: El Linfoma de células B, rara vez se
manifiesta en pacientes inmunocompetentes, pudiendo simular hemorragias o
tumores intracraneales. Nuestra revisión de la literatura destaca la rareza de
estos casos y la importancia de distinguir hemorragias intracraneales como
manifestación del Linfoma de células B.
Conclusión: Las manifestaciones neurológicas del linfoma
de células B es poco común en inmunocompetentes, por lo que presentamos un caso
raro de hematoma subdural agudo no traumático de rápida evolución a la muerte
encefálica.

0079 ESTENOSIS BILIAR EN EL
POSTOPERATORIO DE TRASPLANTE HEPÁTICO
SS Benavides
Mariño(1), MF Amieva(2), G Ramos(2), C Tonelli(2), M Ducasa(2), CB Cozzani(2),
V Picolla(2), A Couso(2), AB Canedo Bermudez(2), ML Ortiz(2), SG Pello(2)
(1) General De Agudos Dr.cosme Argerich. (2)
General De Agudos Dr. Cosme Argerich.
Introducción: El TH es la opción terapéutica curativa para
la enfermedad hepática terminal. Dentro de complicaciones post-trasplante, la
afección de la vía biliar(VB), es una de las más frecuentes, y de mayor
morbimortalidad (10-15%).
Presentacion de Casos Clínicos: Se describen tres pacientes masculinos en POP
de TH de donante cadavérico, usando la Técnica de reconstrucción de la VB por
colédoco-colédocoanastomosis.
Caso 1 (55 años) antecedentes de HBV, Child C, Meld 28,
Tiempo de isquemia fría(TIF) 228 minutos. Presenta débito bilioso por drenajes
y falla multiorgánica, sin evidencia de dilatación de VB por ecografía y CPRE
fallida. Se coloca drenaje por vía percutánea, evoluciona con shock séptico
refractario secundario a colangitis, se produce el óbito en día 11.
Caso 2 (54 años) antecedentes de HCV, Child C, TIF 400
minutos. Evoluciona con encefalopatía, síndrome colestásico y abundante débito
por drenajes, asociado a líquido libre perihepático y VB dilatada por
ecografía. Se realiza CPRE con evidencia de estenosis y fístula biliar, se
coloca drenaje interno/externo con evolución favorable.
Caso 3 (53 años) antecedentes de HCV, Hepatocarcinoma, Child
A y MELD por vía de excepción. TIF 346 minutos. Presenta síndrome colestásico
con VB dilatada por ecografía, y CPRE con evidencia de estenosis biliar(EB). Se
coloca stent a la anastomosis, y evoluciona favorable.
Discusión: Los factores de riesgo para las EB incluyen
la trombosis de la arteria hepática(AH), la colangitis esclerosante primaria,
los donantes añosos, así como el uso de vasopresores. La EB pueden ser
anastomótica, de origen quirúrgico;o no anastomótica, generalmente secundario a
la lesión isquémica del conducto. Clínicamente se presenta como un síndrome
colangítico(C1) o, colestásico(C2/C3). El diagnóstico se realiza por ecografía,
el cual evalúa la alteración del flujo de la AH (indemne C1/C2/C3), o la
dilatación de la VB, proximal a la anastomosis (C1/ C2) o distal (C3). El
tratamiento se limita al drenaje de la VB, por vía percutánea o por CPRE.
Conclusión: A pesar de la alta incidencia de
complicaciones de la VB, el drenaje (Kher) preventivo no está indicado. El
reconocimiento y el tratamiento oportuno reducen el riesgo de morbimortalidad
postoperatoria.


0080 BACTERIEMIA POR
RHODOCOCCUS EN PACIENTE INMUNODEPRIMIDO
FR Dipaolo(1),
Granadero Baigorria, Santa Fe, Argentina, M Latimori(1), Granadero Baigorria,
Santa Fe, Argentina, F Garavelli(1), Granadero Baigorria, Santa Fe, Argentina,
M Ramirez Colombres(1), Granadero Baigorria, Santa Fe, Argentina, C Maenza(1),
Granadero Baigorria, Santa Fe, Argentina, M Re(1), Granadero Baigorria, Santa
Fe, Argentina, S Gattino(1), Granadero Baigorria, Santa Fe, Argentina, N
Rocchetti(1), Granadero Baigorria, Santa Fe, Argentina, C Settecase(1),
Granadero Baigorria, Santa Fe, Argentina, D Bagilet(1), Granadero
Baigorria, Santa Fe, Argentina
(1) Hospital Escuela Eva Perón. (2) Granadero Baigorria. (3) Santa Fe. (4)
Argentina.
Introducción: El Rhodococcus equi (coco de color rojo), es
un cocobacilo Gram positivo pleomórfico, aerobio estricto y ácido alcohol
resistente, que produce un pigmento rojo en los cultivos, de ahí su nombre. Ha
sido reconocido como un patógeno animal, causante de bronconeumonía subaguda o
crónica. La mayoría de las infecciones humanas se han asociado con disfunción
del sistema inmunitario.
Caso clínico: Varón de 56
años, con diagnóstico reciente de VIH y hepatitis B, ingresa por cuadro clínico
interpretado como infarto agudo de miocardio sin lesiones coronarias
obstructivas (myocardial infarction with non-obstructed coronary arteries,
M.I.N.O.C.A). Además, el paciente refiere tos con expectoración purulenta,
fiebre y pérdida de peso de 3 meses de evolución. Examen físico:
Hemodinámicamente estable, febril, SaO2 98% (0,21%). Murmullo vesicular
conservado, sin ruidos agregados, no utiliza musculatura accesoria.
Laboratorio: Hemoglobina 9,2 gr/dl, leucocitos 7900 /mm3, VES 26 mm/1ra hora,
PCR 2,7 mg/dl, procalcitonina 0,18ng/ml, urea 61 mg/dl, creatinina 1,25 mg/dl,
GOT 106 mUI/l, LDH 245 U/l, CPK 178 mUI/l, troponina T 0,369 ug/l, ProBNP 3738
pg/ml, PCR para SARS CoV2 positiva. Radiografía de tórax: imagen cavitada en
campo medio pulmonar izquierdo. Inicia tratamiento con diltiazem y enoxaparina
para M.I.N.O.C.A. Se toman hemocultivos y muestra respiratoria positivos a
Rhodococcus sp., BAAR negativo. Tomografía de tórax, abdomen y pelvis con
contraste: nódulo pulmonar derecho de 15mm y otras dos imágenes de similares
características en campo pulmonar izquierdo, una de ellas cavitada, de 17mm y
otra de 5mm. Ecocardiograma: sin vegetaciones. Inicia tratamiento dirigido con
imipenem y levofloxacina por 14 días, asociado a tratamiento anti-retroviral,
con buena evolución.
Discusión: La infección por R equi es una complicación
oportunista poco frecuente de la infección por el VIH y se presenta en estadios
avanzados de inmunodepresión. La manifestación clínica más frecuente en
pacientes inmunodeprimidos es la neumonía cavitada asociada a bacteriemia en un
80% de los casos y sus síntomas principales son fiebre, pérdida de peso, tos
con expectoración mucopurulenta.
Conclusiones: El diagnóstico precoz, el tratamiento
antimicrobiano adecuado y el inicio del tratamiento anti-retroviral en forma
temprana pueden mejorar la evolución y el pronóstico de esta enfermedad con
alta mortalidad.
FR Dipaolo(1),
Granadero Baigorria, Santa Fe, Argentina, L Marcos(1), Granadero Baigorria,
Santa Fe, Argentina, G Florencia(1), Granadero Baigorria, Santa Fe, Argentina, RC Maria(1), Granadero
Baigorria, Santa Fe, Argentina, M Carolina(1), Granadero Baigorria, Santa Fe,
Argentina, R Melisa(1), Granadero Baigorria, Santa Fe, Argentina, G
Silvana(1), Granadero Baigorria, Santa
Fe, Argentina, R Nicolas(1), Granadero Baigorria, Santa Fe, Argentina, S
Claudio(1), Granadero Baigorria, Santa Fe, Argentina, B Daniel(1), Granadero
Baigorria, Santa Fe, Argentina
(1) Hospital Escuela Eva Perón. (2) Granadero Baigorria. (3) Santa Fe. (4)
Argentina.
Introducción: El status epiléptico refractario de reciente
comienzo (NORSE New-onset refractory status epilepticus) se caracteriza por su
inicio “de novo” sin una causa estructural, tóxica o metabólica específica. El
síndrome epiléptico relacionado con infección febril (FIRES Febrile infection
related epilepsy syndrome) es una subcategoría de éste que requiere una
infección febril previa entre dos semanas y 24 horas antes del inicio del
status, pudiendo o no constatarse fiebre al inicio del mismo.
Caso clínico: Mujer de 21 años, asmática y obesa, ingresa a
la UCI por deterioro de la conciencia y convulsiones tónico-clónicas
generalizadas asociadas a fiebre, diarrea, vómitos y cefalea de 1 semana de
evolución. Examen físico: Hemodinámicamente estable, febril, SatO2 98% (0.21%),
GCS 12/15, sin signos meníngeos. Laboratorio: hemoglobina 9,9 gr/dl, leucocitos
10100 /mm3, procalcitonina 0,06 ng/ml, glucemia 104 mg/dl, urea 30 mg/dl,
creatinina 0,93 mg/dl, sodio 144 mEq/l, potasio 3,9 mEq/l, cloro 107, calcio
8,3 mg%, fosforo 4,2 mg%, magnesio 2,5 mg, TSH 0,66 uUl/ml, FAN y factor
reumatoideo negativos, C3 y C4 normales. Líquido cefalorraquídeo: Leucocitos:
3, glucosa 0,72 g/l, proteínas 0,5g/l, lactato 2,2, VDRL negativa. Hemocultivos
y cultivo de líquido cefalorraquídeo: negativos. Tomografía y RMI de encéfalo
sin contraste: sin alteraciones. EEG: Actividad basal theta con usos de sueños
simétricos, foco de espigas central izquierdo de escasa recurrencia en todo el
registro, patente epileptógena focal. Inicia aciclovir y ceftriaxona, que se
suspenden al obtener resultados de estudios complementarios. A pesar del
tratamiento con fenitoína (fenitoínemia normal) persisten convulsiones, por lo
que se vincula a VM e inicia benzodiazepinas y levetiracetam, sin respuesta. Se
solicitan anticuerpos anti MDA (negativos) e inicia pulsos de metilprednisola
más tiopental, con disminución de las crisis. Luego de 30 días complica con
shock séptico y fallece.
Comentario: El FIRES se caracteriza por convulsiones
refractarias a los antiepilépticos. Algunas ceden temporalmente con coma de
supresión inducido por fármacos. Otras terapias tienen un beneficio limitado.
Conclusiones: El FIRES tiene una baja incidencia, con una
mortalidad del 30% y secuelas neurológicas graves. Si bien su mayor prevalencia
es en edad pediátrica, es un diagnóstico por considerar cuando el status es
refractario al tratamiento.
0082 PRUEBA DE EJERCICIO
CARDIO-PULMONAR Y SPECT PULMONAR V/Q POSITIVO EN PACIENTES POST-COVID
LG Duran(1), L
Melatini(2), Bahía Blanca (ineus), T Papucci(2), Bahía Blanca (ineus), JM Via
Alvarado(2), Bahía Blanca (ineus), M
Colucci(2), Bahía Blanca (ineus)
(1) Hospital Municipal De Agudos Dr. Leónidas
Lucero - Departamento De Ciencias De La Salud (uns). (2) Instituto
Neumonológico Del Sur. (3) Bahía Blanca
(ineus).
Introducción: La práctica médica durante la pandemia
COVID-19 se ha visto fuertemente demanda por sintomatología asociada a dicha
enfermedad. En muchos de los casos estos síntomas no se correlacionaron con
anormalidades evidentes en estudios diagnósticos habituales. Es ampliamente
conocida la predilección del daño pulmonar asociado a esta infección viral,
reconociéndose la lesión vascular pulmonar (que incluye fenómenos como lesión
endotelial, desregulación del tono vascular pulmonar y microtrombosis in situ)
como una entidad a considerar. El objetivo del presente estudio es describir
las características de la prueba de ejercicio cardiopulmonar y el spect
pulmonar v/q patológico en pacientes post COVID.
Población y métodos: Análisis retrospectivo de una cohorte de
pacientes post COVID con centellograma positivo estudiados en el Instituto
Neumonológico del Sur de Bahía Blanca. Criterios de inclusión: Pacientes
mayores a 18 años, COVID documentado por PCR/antígeno, con disnea en cualquier
clase funcional, que se realizó PECP y SPect V/Q pulmonar positivo para MisMach
(Alteración de perfusión con ventilación conservada).
Resultados: Se incluyeron 32 pacientes postCOVID con centellograma positivo. De
esos 32 pacientes, el 87.5% (28/32) fueron del sexo femenino. La media de edad
fue de 42.66 años (DS:12.48). El peso promedio es 68.78kg (DS 12.48).
Analizando se encontró que la media de VE.VCO2 Slope es de 33.09 (IC 32.42 -
33.76). Al comparar las medias de esta variable según el sexo se obtiene un valor
p de 0.848.
Discusión: La causa de este MisMach-V/Q está en debate.
Basados en la bibliografía podría corresponder a un trastorno en vasos
pulmonares de pequeño diámetro con daño endotelial y microtrombosis como efecto
directo de la infección por COVID. Estos pacientes tuvieron una disminución de
la capacidad funcional demostrada por VO2 pico menor al valor predicho normal.
Se evidencio escasa disminución del espacio muerto estimado en VO2 max. Se
evidencio ineficiencia ventilatoria por Ve/VeCO2 elevados
Conclusión: La prueba de ejercicio cardiopulmonar podría
ser un estudio predictor y no invasivo de alteraciones en la circulación
pulmonar. La limitación del estudio radica en que no se realizó estudios de
centellografía pulmonar a pacientes postCOVID asintomáticos y /o con PECP
dentro de parámetros normales.
DA Rodriguez(1), P
Centeno(1), M Petre(1), F Puzzo(1), M Anchorena(1), J Aldana Diaz(1), D Ortega
Rodriguez(1), L Sanabria(1), X Benavente(1)
(1) Hospital De Alta Complejidad Del
Bicentenario De Esteban Echeverría.
Introducción: Los pulmones son los órganos que mayor
dificultad presentan para ser trasplantados. Los criterios de selección son
estrictos ya que su posterior implantación es dificultosa.1-3 En Argentina,
durante 2021 se realizaron 23 trasplantes bipulmonares y 12 trasplantes
unipulmonares. Al 16 de febrero de 2022 se encuentran 286 sujetos en lista de
espera de trasplante de pulmón en nuestro país, lo que refleja una acentuada
diferencia entre receptores y donantes.4 El objetivo del presente estudio es
describir las características clínico-demográficas de los pacientes donantes
reales y evaluar la relación entre los potenciales donantes de pulmón respecto
a los donantes reales efectivos de pulmón en un Hospital público de la
República Argentina.
Material y método: Estudio de diseño descriptivo. Los datos se
obtuvieron de la historia clínica electrónica. Se incluyeron pacientes donantes
reales de nuestra institución entre el 1ro de enero y el 31 de diciembre de
2021. Se realizó un análisis de todas las variables demográficas necesarias
para poder clasificarlos como potenciales donantes de pulmón según los
criterios de la Sociedad Española de Trasplante. Se realizó un análisis
estadístico de tipo descriptivo.
Resultados: Se incluyeron 42 pacientes donantes reales,
de los cuales 29 (69%) fueron efectivos. En la tabla 1 se encuentran las
características clínico-demográficas. Aplicando los criterios de elegibilidad
se identificaron 15 sujetos potenciales donantes de pulmón, de los cuales 9
cumplían criterios ideales y 6 criterios como donantes marginales. La tabla 2
compara aquellos pacientes que cumplen criterios como potenciales donantes de
pulmón respecto a los que no los cumplen. De los pacientes identificados como
potenciales donantes y presentados como candidatos a ablación de pulmones
solamente 2 (13%) fueron aceptados e implantados.
Conclusión: En el Hospital del Bicentenario de Esteban
Echeverría durante el año 2021 fueron aceptados e implantados el 13% de todos
los pulmones que cumplían criterios de ablación, un porcentaje extremadamente
bajo teniendo en consideración la dificultad que presentan los pulmones para
ser aptos de ablación. Esto nos lleva a cuestionar cuál es el motivo por el
cual se rechazan los pulmones ofrecidos y que medidas deben adoptarse para
aumentar la cantidad de órganos ablacionados.


DA Rodriguez(1), P
Centeno(1), F Puzzo(1), L Sanabria(1), B Murguía(1), M Petre(1), M Domanico(1),
E Duarte(1), M Anchorena(1)
(1) Hospital De Alta Complejidad Del
Bicentenario De Esteban Echeverría.
Introducción: Con el pasar
del tiempo se han ido modificando los criterios de selección de pulmones aptos
para procuración e incluso se han determinado criterios marginales con el fin
de aumentar la cantidad de potenciales donantes de pulmón. Esta flexibilización
en los criterios de selección no ha mostrado diferencias significativas en la
mortalidad a largo plazo de los pacientes en los que se implantaron dichos
órganos.1-3 A pesar de las modificaciones, el índice PaO2/FiO2 continúa siendo
la única herramienta de valoración del estado del pulmón junto a la radiografía
de tórax. El objetivo de este estudio es describir variables modernas que permitan
identificar el estado del pulmón en un grupo de pacientes potenciales donantes
de pulmón en un Hospital Público de la República Argentina.
Materiales y Métodos: Estudio de diseño descriptivo. Los datos se obtuvieron de la historia
clínica electrónica. Se incluyeron pacientes con diagnóstico de muerte
encefálica que hayan cumplido criterios de potenciales donantes de pulmón según
los criterios de la Sociedad Española de Trasplante; y que hayan sido
internados en nuestra institución entre el 1ro de enero y el 31 de diciembre de
2021. Se realizó el análisis de las siguientes variables: Índice PaO2/FiO2,
Complacencia del Sistema Respiratorio, Ratio Ventilatorio e Índice a/A.
Resultados: Se incluyeron
15 pacientes de los cuales 9 (60%) cumplían criterios ideales y 6 (40%)
criterios marginales como donantes de pulmón. En la tabla 1 se observan las
características clínico demográficas. De los 6 que cumplían criterios
marginales, cuatro fueron por tiempo mayor a 72 hs de de VM, uno por PaO2/FiO2
< 300 y otro por ser tabaquista < a 20 p/year. En la Tabla 2 se describen
las variables de resultado y el setting ventilatorio de los pacientes
incluidos.
Conclusiones: Se
describieron los resultados y se observó que a pesar de tener una buena
relación PaO2/FiO2 existe una gran variabilidad en las demás variables. Lo que
lleva a plantear los siguientes interrogantes: ¿La variable PaO2/FiO2 en forma
independiente puede definir la calidad de un pulmón?; ¿Habría que incorporar
nuevas variables a la hora de elegir un potencial donante de pulmón?


DA Rodriguez(1), P
Centeno(1), M Petre(1), R Canelon(1), L Boffino(1), L Sanabria(1), E
Montiel(1), M Anchorena(1)
(1) Hospital De Alta Complejidad Del
Bicentenario De Esteban Echeverría.
Introducción: La parada circulatoria cerebral inicia una
cascada proinflamatoria que deteriora la función de los órganos. A nivel
respiratorio el aumento de la presión intravascular daña las células alveolares
y aumenta la permeabilidad vascular. La ventilación mecánica (VM) genera stress
y aumenta la circulación de mediadores inflamatorios. La inactividad muscular y
el supino predisponen a atelectasias, alteración de la mecánica ventilatoria y
del intercambio gaseoso. La inflamación, la caída de la oxigenación y las
alteraciones hemodinámicas afectarán al resto de los órganos, disminuyendo su
calidad o incluso haciéndolos inviables para el trasplante. La ventilación del donante
busca preservar el pulmón y disminuir el daño generado por la VM. Existe
evidencia que demuestra los beneficios del decúbito prono en pacientes con
Síndrome de Distrés Respiratorio Agudo: Mejoría del intercambio gaseoso,
aumento de la capacidad residual funcional, optimización de la perfusión,
disminución del stress pulmonar y de la compresión del mediastino. Considerando
la dificultad para obtener pulmones para trasplante, el uso del decúbito prono
en potenciales donantes revertiría los efectos deletéreos descriptos aumentando
la disponibilidad de pulmones aptos para donación. El objetivo de este trabajo
es reportar el caso de un paciente al que se le aplicó decúbito prono desde el
diagnóstico de la ME.
Material y Método: Estudio de tipo reporte de caso.
Presentación del caso: Masculino, 25 años, sin antecedentes
relevantes, cursando otitis crónica (45 días). Admitido por convulsiones
tónico-clónicas, sin recuperación posterior. Glasgow score 3/15. Se identificó
absceso cerebral contigüo a oído interno y edema generalizado. Se diagnosticó
cese irreversible de las funciones encefálicas dentro de las 24 horas de
internación. Recibió desde el ingreso tratamiento antibiótico. Al día 1 de VM
presentaba PaO2/FiO2 287 y Csr 46ml/cmH2O. Se instauró el decúbito prono. Al
día 2 de VM presentaba PaO2/FiO2 509 y Csr 63,7 ml/cmH2O (Figura 1). No
requirió vasopresores ni presentó disfunciones orgánicas. Cumplidas 48 horas de
tratamiento antibiótico se distribuyeron los pulmones.
Conclusión: El decúbito prono mejoró la mecánica del
sistema respiratorio como el intercambio gaseoso. El paciente pasó de cumplir
criterios marginales a criterios ideales para donar pulmones y fue aceptado
para distribución de sus órganos.

0087 MENINGITIS POR
FEOHIFOMICOSIS EN PACIENTE CON TRASPLANTE DE ORGANO SOLIDO
A Gira(1), F
Monsalve(1), D Czerwonko(1), P Falvo(1), D Monardo(1), P Pratesi(1)
(1) Universitario Austral.
Introducción: La Feohifomicosis, enfermedad emergente, su
factor de virulencia esta dada por melanina en la pared celular, en Trasplante
de Órganos sólidos (TOS) la incidencia es de 0,7%, aumenta con el uso de
tacrolimus al 2,6% y la mortalidad es del 27-65%.
La forma de presentación cutánea es del 50%.
La presentación neurológica: absceso,
meningitis, encefalitis, mielitis, posee una mortalidad del 64%, se asocian
Cladosporium, curvularia, verruconis, exophiala, fonsecaea.
Presentación del caso: Mujer de 54 años, trasplantada renal donante
cadavérico en 2018 (GNRP ANCA P+), inmunosuprimida con micofenolato, tacrolimus,
meprednisona.
Ingresa por guardia con fiebre, diarrea y
convulsiones, se realiza Tc cerebro sin lesión y Tc tórax con neumonía, LCR
(incoloro, Leucocitos 63, proteínas 183, hipoglucorraquia) y cultivo negativo
inicia Vancomicina, Cefepime, Ampicilina y Ganciclovir), requiere ARM, se
realiza BAL. EEG de ingreso sin descargas y a las 72 has Status convulsivo.
A los 10 días del BAL se aísla Cladosporium
spp inicia Voriconazol y a las 48hs se constata EEG sin descargas.
Biopsia de lesiones de piel: inespecífica y
cultivo negativo. A los 45 días pasa a clínica medica
Discusión: Los test serológicos de galactomananos no son
utiles ya que no son producidos por estos hongos , las pruebas de B y D glucano
en sangre y LCR si poseen alta sensibilidad y especificidad. En nuestro caso se
realizó diagnostico por el BAL.
Conclusiones: Aunque posee alto neurotropismo no se aisla
fácilmente, realizar pruebas de B y D glucano es una buena opción que ayuda al
diagnostico.
MV Saucedo(1), NC
Rumbo(1), I Castro(1), SV Santarelli(1), CE Lopez(1), E Barimboin(1), E
Zirulnik(2), SS Alvarez(1)
(1) Central De Mendoza. (2) Fundación Escuela
Medicina Nuclear.
Objetivos: Evaluar calidad de vida (encuesta EUROQOL-5D)
en pacientes que presentaron afectación intersticial en el contexto de NAC por
COVID 19.
Métodos: Sobre 15 pacientes internados en UTI entre
julio 2021 y enero 2022, con diagnóstico de NAC por SARCOV 2 con imágenes
sugestivas de enfermedad inflamatoria intersticial, que recibieron 3 dosis de
metilprednisolona EV, (entre los 15-30 días de su FIS), se siguieron a los 7
sobrevivientes y se les realizó EUROQOL-5D con el Termómetro EUROQOL del Estado
de Salud (instrumento genérico de medición, en el que el propio individuo
valora su estado de salud por dimensiones y escala visual), clínica y nueva TC
de tórax revisadas por experto radiólogo.
Resultados: 10 pacientes son mayores de 50 años. 11
varones, 14 tenían comorbilidades. Sólo 5 pacientes estaban vacunados, de los
cuales 1 sobrevivió.
En cuanto a los patrones radiológicos (entre
6 meses-1 año) de los sobrevivientes: 4 pacientes con patrón fibrótico e
inflamatorio, 2 patrón inflamatorio, 1 con grave secuela fibrótica. De los 7
pacientes que sobrevivieron, 4 realizaron rehabilitación por lo menos 2 meses.
En EQ-5D, el máximo nivel de calidad de vida
se expresa con un valor absoluto de 1 con un mínimo de 0, equivalente a el peor
estado de salud imaginable. Incluye 5 dimensiones: movilidad, cuidado personal,
actividades cotidianas, dolor/malestar, ansiedad/depresión. 2 pacientes,
tuvieron un valor de 1 con un termómetro que oscilaba entre 90-100 puntos. 3
entre 0.9 a 0.7, con un termómetro entre 50-90; 2 menor a 0.12 con un
termómetro de 50.
Conclusiones: Ésta encuesta es una herramienta fácil de
aplicar (por vía presencial, telefónica o email), para la evaluación de calidad
de vida en los pacientes post UCI con esta condición clínica.


S Gasparotti(1), LM
Rodriguez(1), FP Bertoletti(1)
(1) Clinica San Jorge.
Introducción: La tuberculosis (TB) es una enfermedad
infecciosa inflamatoria granulomatosa. En Argentina en 2020 se notificaron
10.896 casos, el 76,9% fueron pulmonares y el 23.1% extra pulmonares.
El 10% de las pericarditis son tuberculosas y
representan entre el 1% y el 4% de las formas de TB, con alta mortalidad sin un
diagnóstico y tratamiento correcto. La clínica incluye fiebre, disnea, dolor
torácico, palpitaciones, pérdida de peso, pulso paradójico, ingurgitación
yugular, signo de Kussmaul y frote pericárdico.
El diagnóstico de PT se realiza al
identificar el bacilo de Koch en el líquido o tejido pericárdico siendo la
biopsia de mayor rédito diagnóstico.
Presentación del caso: Paciente masculino de 25 años, consulta por
síncope.
Refiere tos de 4 meses de evolución, sudoración nocturna y pérdida de
peso. Se realizó Rx, Tac de tórax ecocardiograma con derrame pericárdico severo
y pericardiocentesis con toma de muestra y biopsia.
En nuevo ecocardiocardiograma se constata
derrame pericárdico tabicado. Se decide iniciar tratamiento empírico antituberculoso
por alta sospecha clínica. Se realiza drenaje pericárdico trans-diafragmatico
quirúrgico. Evolución favorable.
Se recibe informe de biopsia y líquido
compatible con PT.
Discusión: La pericarditis tuberculosa es de difícil
diagnóstico, requiere de pericardiocentesis o biopsia, dado su bajo rédito de
los cultivos. El 75% de las PT tiene diagnóstico confirmado y el 25% se
considera subdiagnosticado (diagnóstico respaldado por respuesta al tratamiento
antifímico empírico).
El tratamiento recomendado es la
administración combinada de Rifampicina, Isoniacida, Piracinamida y etambutol.
La adición de corticoesteroides es
controversial.
La pericardiectomía solo se reserva en la
pericarditis constrictiva o taponamiento cardíaco recurrente.
En nuestro caso se decidió iniciar
tratamiento antifímico por alta sospecha clínica, y reproducción del derrame.
No se realizó corticoterapia. Se realizó drenaje quirúrgico del pericardio.
Conclusión: La TB es una
enfermedad frecuente en Argentina. En el diagnóstico diferencial de
pericarditis debe sospecharse la TB por su frecuencia y su alta tasa de
mortalidad en ausencia de tratamiento y ante su sospecha clínica debe iniciarse
su tratamiento empírico.

0090 Aspergilosis pulmonar
asociada a COVID-19: una mirada retrospectiva
NI Zelaya De
Leon(1), CJ Beroiza(1), M Cruz(1), LG Duran(1), NA Grassi(1), AV Millán(1), MG
Montenegro Fernandez(1), M Petasny(1), P Zorzano Osinalde(1)
(1) Hospital Municipal De Agudos Dr Leonidas
Lucero.
Introducción: La aspergilosis pulmonar invasiva es una
infección fúngica oportunista, desarrollada principalmente en pacientes
inmunocomprometidos. Durante la pandemia por SARS-CoV-2, la incidencia de
aspergilosis pulmonar se vio aumentada, dando origen a una nueva entidad,
denominada “aspergilosis pulmonar asociada a COVID-19”, aunque su diagnóstico
está limitado por la falta de criterios estandarizados. Se estima una
incidencia global del 10% y una mortalidad mayor al 50%. La presencia de
aspergilosis pulmonar invasiva podría tener un impacto negativo en la evolución
de los pacientes con COVID-19.
Objetivo: Describir las características clínicas de
pacientes con aspergilosis pulmonar asociada a COVID-19 internados en la unidad
de terapia intensiva del Hospital Municipal de Agudos de Bahía Blanca.
Métodos: Estudio de cohorte retrospectivo. Se
incluyeron pacientes ingresados en unidad de terapia intensiva con diagnóstico
de COVID-19, que requirieron ventilación mecánica invasiva durante 2020-2021.
Se definió aspergilosis pulmonar asociada a COVID-19 según los criterios del
Centro Europeo de Excelencia en Micología Médica. Los datos fueron recolectados
de historias clínicas digitalizadas. Se realizó un análisis multivariado para
estimar los porcentajes y medias de las variables de interés. Se utilizó la
prueba de chi-cuadrado para medir asociación entre mortalidad y recuento de
CD4, con aspergilosis pulmonar asociada a COVID-19. Para el análisis de medias
se utilizó la prueba U de Mann-Whitney. Se consideró estadísticamente significativo
un p valor menor a 0.05. Para el análisis estadístico se utilizó el software
SPSS-23.
Resultados: Se incluyeron 131 pacientes. El 11,5%
(15/131) de los pacientes tuvieron aspergilosis pulmonar asociada a COVID-19.
Para pacientes sin y con aspergilosis pulmonar asociada a COVID-19, la media de
APACHE-II fue de 15 y 13 (p=0.036), la media de LIS-Murray fue 2.8 y 2.5
(p=0.036), la media de días de asistencia ventilatoria mecánica fue 19.9 y 27.6
(p=0.008), la media de días en terapia intensiva fue 19.9 y 27.9 (p=0.012) y la
media de días de estancia hospitalaria fue 27.4 y 34.4 (p=0.045),
respectivamente.
Discusión y conclusión: A pesar de presentar predictores de gravedad
más bajos, los pacientes con aspergilosis pulmonar asociada a COVID-19 podrían tener
mayor probabilidad de requerir ventilación mecánica prolongada, más días en
terapia intensiva y mayor estancia hospitalaria.
0093 Encefalitis de
Bickerstaff: a propósito de un caso
F Delgado(1), C
Ottaviani(2)
(1) Santa Isabel De Hungria. (2) Hospital
Santa Isabel De Hungria.
Introducción: La encefalitis de Bickerstaff es una
enfermedad neurológica aguda poco frecuente, perteneciente al espectro
patológico del síndrome de Guillain-Barré y del síndrome de Miller-Fisher. Se caracteriza
clínicamente por oftalmoplejia, ataxia, alteración de conciencia y arreflexia.
Presentación del caso: Paciente femenina de 82 años con antecedentes
de hipertensión arterial, hipotiroidismo y ACV isquémico no secuelar, que
consulta por cefalea occipital y mareos, agrega posteriormente ptosis palpebral
izquierda, disartria, ataxia, paresia de miembro superior izquierdo y reflejo
plantar extensor bilateral. Se realiza TC de cerebro sin signos de sangrado ni
isquemia. RMN sin
lesiones agudas. PL con disociación
albúmino-citológica significativa. Progresa con disfagia, mal manejo de
secreciones, tos inefectiva y trastorno de conciencia.
Requiere soporte ventilatorio. Por sospecha
de encefalitis de Bickerstaff se inicia tratamiento con gammaglobulina por 5
días, pendiente GQ1b.
Discusión: La encefalitis de Bickerstaff es una
enfermedad con una baja incidencia anual (0.078 cada 100.000 hab con predominio
masculino 1.3:1) de causa autoinmune, con anticuerpos anti-GQ1b positivos. Se
considera dentro del espectro del síndrome de Guillain- Barré y se lo ha
asociado a patógenos como C. jejuni y H. influenzae (y en menor medida a
Salmonella typhi y paratyphi, M. pneumoniae,
CMV, EBV, HSV, VZV) por mimetismo de
gangliósidos de lipo-oligosacáridos.
Conclusión: Si bien es una enfermedad considerada poco
frecuente, se sospecha encefalitis de Bickerstaff en nuestro caso por la
presentación clínica característica (ataxia, oftalmoplejia, arreflexia, reflejo
plantar extensor bilateral) asociado a disociación albumino-citológica con TC y
RMN de cerebro negativas. Cómo controversia, es importante destacar las
diferencias con el síndrome de Miller Fisher
y síndrome de Guillain-Barré, si bien estan
consideradas dentro del mismo espectro, la patología acá expuesta suele manifestarse
clinicamente de forma descendente y con alteración del estado de conciencia de
forma temprana, con proteinorraquia elevada por mayor daño a la barrera
hematoencefálica.
0094 A PROPOSITO DE UN CASO
INFRECUENTE DE SINDROME SEROTONINERGICO
S Quintana(1), D
Barrientos(1), J Cardozo(1), F Arancibia(1), A Rodriguez(1), N Montaño(1), D
Romero(1), R Altamirano(1), G Rodriguez(1), W Videtta(1), A Tamayo(1), T
Huanca(1), A Barra Montes De Oca(1)
(1) Eva Peron De Merlo.
Introducción: El síndrome serotoninérgico se caracteriza
por la presencia de disfunción autonómica, deterioro neuromuscular y
alteraciones en el estado mental.
Presentación del caso: masculino de 32 años con antecedentes de
trastorno obsesivo compulsivo y esquizofrenia, ingresa por guardia por
presentar deterioro del estado de conciencia secundario a intoxicación
medicamentosa con risperidona 330 mg y fluvoxamina 6 gr de 6 horas de
evolución, al examen físico Glasgow 8/15, pupilas moticas hiporeactivas se
procede a IOT-ARM, es extubado a las 6 hs y posterior traslado a UTI donde se
evidencia a paciente con excitación psicomotriz pupilas mioticas bilaterales,
febril, temblores, clonus, hiperreflexia, diaforesis, taquicárdico, mal manejo
de secreciones, mala mecánica ventilatoria, desaturación e hipotensión que no
responde a cristaloides que requiere de doble esquema vasopresor por lo que se
decide IOT-ARM.
Parámetros laboratoriales, cpk 28850,
troponinas 717, EAB con acidosis metabólica severa, lactico elevado, disfunción
renal que requirió de terapia de remplazo renal.
toxicología del hospital posadas indica
tratamiento con benzodiazepinas, analgesicos, y la ciproheptadina, con
evolución favorable, se inicia weanning en fecha 19/03, y es extubado 26/03.
Conclusión: El síndrome serotoninérgico secundario a
inhibidores de recaptura de serotonina se presenta en algunos casos debido al
empleo indiscriminado de estos medicamentos y sus múltiples interacciones
medicamentosas. Por este motivo debe de tenerse en mente dentro de los diagnósticos
diferenciales en aquellos pacientes que son tratados con estos e ingresan al
hospital con disfunción autonómica, sintomatología neuromuscular y deterioro
neurológico.
E Picos(1), J
Joaquin(2), I Castro(2), R Aranda(2), B Fradin(2), V Fiorentini(2), E Dutto(2),
P Desousa(2), P Staffolani(2), G Frankenberger(2), S Alvarez
(1) Hospital Central. (2) Central.
Introducción: Durante la pandemia por SARSCOV2, la cánula
nasal de alto flujo (CNAF) se usó como soporte en espera de UTI (unidad de
terapia intensiva) o como alternativa a la ventilación invasiva. Su uso fue
controversial por bioseguridad y temor a intubación tardía. El objetivo de este
trabajo es la descripción y análisis del uso de CNAF en nuestra población.
Materiales y métodos: Estudio observacional descriptivo
retrospectivo. 154 pacientes utilizaron cnaf entre octubre de 2020 y marzo
2021; se incluyeron 72 (16 a 88 años), SARSCOV2 positivos, atendidos en Guardia
y UTI.
Los datos fueron analizados por un
profesional externo.
Resultados: *20 mujeres y 52 hombres; comórbidas
principales: Hipertensos (32), obesos (24) y diabéticos (21), sin comórbidas
(9).
*50% de éxito y 50% de fracaso.
Variables analizadas
*Comparación Irox inicio grupo “éxito” vs
grupo “fracaso” p: 0.006 (Test U Mann–Whitney)
*Comparación Irox.12hs grupo “éxito” vs grupo
“fracaso” p < 0.001(Test U Mann– Whitney)
*Comparación “Tiempo desde ingreso a inicio
de CNAF” grupo “éxito” vs grupo “fracaso” p 0.133
*Comparación “Delta IROX” grupo “éxito” vs
grupo “fracaso” p 0.092 (Test U de Mann – Whitney)
Discusión y Conclusión: Predomina sexo masculino, similar a otras
series revisadas.
Principales comórbidas: obesidad, Diabetes,
hipertensión arterial.
50% de los pacientes no requirió ventilación
invasiva.
Las variables “irox de inicio” e “irox a las
12hs” se relacionaron al grupo “éxito” de manera significativa.
Ante la presunción que el inicio precoz se
asociaba a mayor éxito se correlacionaron las variables: “tiempo de ingreso a
inicio de CNAF “/ éxito o fracaso. La diferencia encontrada no fue
estadísticamente significativa.
Ante la presunción de que mejoría del irox se
asociaba a éxito se correlacionaron las variables: “delta irox/éxito o
fracaso”. La diferencia encontrada no fue estadísticamente significativa.
Nos parece interesante en un futuro validar
estos datos en otras patologías a fin de afianzar el manejo de la CNAF.
0097 REPORTE DE CASO,
MUCORMICOSIS GASTROINTESTINAL PEDIÁTRICO
NM Valenzuela(1), MG
Lafuente(1), MA Acuña(1)
(1) Hospital De Pediatría Dr Fernando
Barreyro.
Introducción: La mucormicosis es una micosis oportunista
rara, pero fatal, que afecta a pacientes inmunocomprometidos. Se presenta de
forma rinocerebral, pulmonar, gastrointestinal y diseminada. Debido a su baja
incidencia, difícil diagnóstico y alta mortalidad reportamos el caso de un
paciente, sin inmunodeficiencia que desarrolló la patología.
Presentación del caso: Paciente femenino de 6 meses, etnia guaraní,
que ingresa en esta oportunidad por tos e hipertermia de 24 horas. Al examen
físico constatamos desnutrición y deshidratación severa, sensorio alternante,
taquicardia, taquipnea, saturando 88% con oxígeno por mascara simple, abdomen
sin tumoraciones. Deposiciones abundantes, con múltiples fisuras en región
anal. Por deterioro general ingresa a TIP donde se vincula a ARM, se expande
con cristaloides, se toman cultivos y laboratorio básico: Leucocitosis con
desviación a la izquierda, acidosis metabólica grave, hipokalemia,
hipocalcemia, hipoalbuminemia. ECOGRAFIA ABDOMINAL: asas intestinales
dilatadas, edema de pared, liquido libre abdominal. Se recibe filmarray de
materia fecal positivo para CampylobacterJejuni y Shigella entero invasiva,
evolucionando al shock séptico a foco enteral.
A los pocos días inicia tolerancia oral,
presentando distensión abdominal, con abundante debito bilioso por SNG. Se
repiten imágenes, donde se evidencian neumoperitoneo, líquido libre
particulado, asas distendidas, ingresando a quirófano de urgencia constatándose
perforación en íleon a 20 cm de la válvula ileocecal. Se confecciona
ileostomía. Continuó crítica con requerimiento de inotrópicos por 13 días, ARM
por 20 días y antibioticoterapia dirigida. Al mes, ya en sala general, se
obtienen resultados de anatomía patológica concluyendo en Ileítis granulomatosa
vinculable a micosis profunda (Mucormicosis). Recibió Anfotericina liposomal
durante 21 días. A los 60 días se cierra ileostomía con reconstrucción del
tránsito intestinal. Continuando en seguimiento nutricional.
Discusión: La forma gastrointestinal se da en pacientes
desnutridos e inmunocomprometidos, sin embargo solo se documento linfopenia en
una oportunidad y neutropenia leve durante el periodo de shock séptico. En la
bibliografía se describe como un abdomen agudo de inicio insidioso, que en
nuestro caso fue agudo y súbito, además de perforación intestinal con
peritonitis secundaria.
Conclusión: Debido a la infrecuencia de esta patología,
consideramos importante reportarla para contribuir a la literatura actual.
0098 Sobrevida y estado
funcional al año en pacientes ventilados por COVID 19
G Echavarria(1), M
Gutierrez(1), E Sobrino(1), G Badariotti(1), P Sabaté(1), A Manchado(1), P
Lavorato(1), P Lopez(1), M Durlach(1), I Raguzzi(1), A Luconi(1), G Galego(1),
B De Diego(1)
(1) Mater Dei.
La pandemia de COVID-19 llevó a insuficiencia
respiratoria a millones de personas. Son escasos hasta el momento los datos publicados
sobre la mortalidad y calidad de vida luego de un año de los pacientes que han
estado en asistencia ventilatoria mecánica (AVM) por COVID-19.
Se realizó un estudio ambispectivo
unicéntrico que incluyó a los pacientes internados en la terapia intensiva con
AVM invasiva por insuficiencia respiratoria secundaria a SARS-CoV2 entre el
01/03/2020 y el 31/08/2021. Se registró: variables demográficas, score de
Charlson, SOFA y APACHE II, soporte ventilatorio previo, tratamientos
recibidos, coinfecciones y complicaciones para calcular la mortalidad
hospitalaria y las variables asociadas y realizar seguimiento al año de los
pacientes dados de alta vía entrevista telefónica a fin de determinar
mortalidad, estado funcional mediante índice de Barthel y sensación de disnea
con escala de mMRC.
Un total de 110 pacientes fueron incluidos
(edad 64 años [29–88]; 71% masculinos). SOFA y APACHE II al ingreso fueron de
3.86 (DS 1.28) y 13.53 (DS 4.88) respectivamente. El 55% recibió soporte no
invasivo previamente a la internación, el 36.6 % con cánula nasal de alto
flujo. La mortalidad intrahospitalaria fue de 35.45%. En el análisis
multivariado los factores predictores de mortalidad fueron: edad [Odds Ratio
[OR] per 1-year aumentaba 1.04, 95% CI 1.005–1.09), el desarrollo de
insuficiencia renal [OR 2.96, 95%CI 1.48 -2.17] y la ventilación en prono como
expresión de gravedad [OR 3.96, 95% CI 1.33-11.76]. Luego del alta
hospitalaria, 4 pacientes fallecieron (mortalidad al año de 39%).
El 91% de los sobrevivientes respondió la
entrivista a los 12 meses. El 95,08% al año no tenían ninguna incapacidad o
esta era ligera al ser evaluados por la escala de Barthel, y la valoración de
disnea en este grupo según la escala mMRC era de menor a 2 (en esfuerzos
moderados o intensos) en el 80,6%.
La mortalidad intrahospitalaria se halló
asociada a la edad, a falla renal aguda, y al requerimiento de ventilación en
prono. Al año la sobrevida disminuyó en forma modesta y la mayoría de los
pacientes tienen vida independiente y con escasa sintomatología de disnea.


I Fernández
Ceballos(1), E Steniberg(1), JM Nuñez Silveira(1), J Ems(1), M Madormo(1), I
Carboni Bisso(1), MJ Las Heras(1), JF Sinner(1)
(1) Hospital Italiano De Buenos Aires.
Introducción: El Trasplante bipulmonar es el tratamiento de
elección en pacientes EPOC en etapa terminal. Ante escasez de órganos, se
recurre al trasplante unipulmonar (TUP). El soporte ventilatorio es un desafío,
dado que el sistema respiratorio contiene pulmones con diferente elastancia. La
tomografía por impedancia eléctrica (TIE) valora la distribución global y
regional del aire pulmonar. Se presentan 2 situaciones clínicas.
Caso clínico: Paciente EPOC, que cursa posoperatorio de
TUP. A las 24 hs intercurre con disfunción del graft.
Postoperatorio inmediato: Monitoreo
ventilatorio convencional VT 6 ml/kg, PEEPt 11, Pplat 18, Driving pressure (DP)
7. La TIE evidenció distribución heterogénea de la impedancia tidal (Tz),
correspondiendo el 87,3% al pulmón nativo (PN). La complacencia regional fué:
PN 44,9 vs PT 6,5 ml/CmH20. El incremento del VT y PEEP, aumentaron el índice
de inhomogeneidad (Iindex) (0.57 y 0.58 respectivamente). En decúbito lateral,
con el PN más declive,, el Iindex mejoró (0.4), el VT del pulmón trasplantado
(PT) aumentó un 204 % (+ 92 ml) y aumentó 243% la complacencia regional del PT
(22.3 vs 6,5%).
Destete: Se aplicó alto flujo por vía nasal
(AFCN) y traqueal (AFT), evidenciando en el PN un aumento de la impedancia de
fin de espiración (EELI) regional (+15,1% y +23.3%), disminución del Tz (-7,6%
y -17,8%), y un aumento de espacios silentes ( +48.3% y +25,5%), reflejando
hiperinsuflación dinámica y atrapamiento aéreo regional. El PT presentó
disminución del Tz (-18,9%), aumento de los espacios silentes (+ 53.6%), sin
cambios en la EELI, traduciendo hipoventilación.
Discusión: La distribución del volumen pulmonar fue
heterogénea y el monitoreo ventilatorio convencional no reflejó los cambios
regionales. Las estrategias ventilatorias protectoras convencionales
promovieron el atrapamiento aéreo en el PN sin beneficios en el PT. La
aplicación AFCN y AFT promueve la hiperinsuflación dinámica provocando
atrapamiento aéreo en el PN e hipoventilación del PT.
Conclusión: En el TUP, la TIE brinda información de la
distribución regional del volumen pulmonar, pudiendo evaluar en cada pulmón por
separado el impacto de la estrategia ventilatoria y la oxigenoterapia.
K Velazquez(1), L
Huespe(1), L Ojeda Flores(1), L Solis(1), M Gonzalez(1), LB Costa(1), C
Pisarella(1), M Perez Scetti(1), C Mizdraji(1), S Lazzerri(1), JE Alfonso(1), H
Alvarez(1), M Bovetti(1), L Rodriguez(1), CJ Segovia(1)
(1) Hospital Escuela Gral. San Martin.
Introducción: La miopatía diafragmática es una de las
complicaciones frecuentes en paciente con infección severa por COVID-19.
Presentación de caso: Paciente de 42 años.
Antecedente de internación por COVID-19. Evoluciona el 08/01/2021 con disnea CF
II, mialgias y dolor abdominal. Se realiza TC de tórax que evidencia infiltrado
alveolar bilateral, derrame pleural y pericárdico leve. El 20/01/2021 por
presentar disnea CF III es internado en sala general. Por progresar a disnea CF
IV se interna en Terapia Intensiva. Gasometría pH: 7.10; PCO2: 115mmHg, PO2 138
mmHg. Se asume como Insuficiencia respiratoria aguda hipercápnica. Se decide su
intubación. Tras 48 hs de ventilación mecánica se inicia el destete de la
ventilación mecánica. Evoluciona con destete dificultoso por lo que se realiza
traqueostomía precoz. Se realiza ecografía que informa excursión diafragmática
de 0.9 mm del lado izquierdo y 0.5mm del lado derecho. Se coloca balón
esofágico con las siguientes mediciones P 0.1: 4, pEs de 8, Vt 6.3 lts/min, F.R
de 14. Se asume como miopatía diafragmática. Tras 6 meses de internación en
UTI, se decide su alta. Despúes de 7 meses de soporte ventilatorio, el
20/12/2021 se desvincula de la ventilación mecánica y el 20/01/2022 se efectua
su decanulación exitosa.
Discusión: Los pacientes con ventilación mecánica
desarrollan con frecuencia debilidad diafragmática. Estudios científicos han
demostrado que los pacientes con COVID-19 presentan distintos cambios
miopáticos en el diafragma.
Conclusión: Nuestro caso tiene la importancia de destacar
a la miopatía diafragmática como causa de disnea progresiva en paciente post
COVID-19.
ML Cazzola(1), MS
Ocampo(1), MV Benito(1), MB Mijalski(1), A Cremona(1)
(1) Hospital Italiano De La Plata.
Introducción: La pandemia (P) de SARS-CoV2 ha agravado la
resistencia bacteriana y la producción de carbapenemasas a nivel mundial. El
Instituto INEI Malbran emitió un alerta epidemiológico a cerca de la emergencia
de enterobacterias dobles productores de carbapenemasas (EDPC).
Objetivo: Evaluar la presencia de EDPC y la prevalencia
de C detectadas en bacilos gram negativos (BGN) de hemocultivos (H) tomados en
la unidad de cuidados intensivos (UCI) del 1 de enero (E) de 2018 al 30 de
junio (J) de 2022.
Materiales y métodos: Estudio retrospectivo observacional
descriptivo donde se estudiaron las C de 798 BGN provenientes de los H tomados
entre el 1 de E de 2018 y el 30 de J de 2022 en la UCI del hospital. La
clasificación del tipo de C se realizó mediante pruebas de inhibición
(sinergia) con monodiscos de ácido borónico y EDTA, colocación estratégica de
discos combinados de meropenem DCMBrit y método inmunocromatográfico RESIST- 3
O.O.K. K-SeT Britania.
Resultados: Distribución de C en BGN de H de UCI.

Conclusión: El % de BGN aislados de H de UCI que
presentaron algún tipo de C aumentó de 0% en Jl_D2018 a 39% en E_J2021. En el
período post-pandemia el % de C se mantuvo en 31-34%. En el período previo a la
P por SARS-CoV2 la C más aislada fue Oxa 163. Durante la P el aumento de C se
dió a expensas del aumento de KPC y MBL, situación que se mantuvo pasada la
segunda ola, sumado al aislamiento de EDPC.
MA Sabbatini(1)
(1) Clinica Del Valle.
Introducción: La traqueostomía es frecuentemente utilizada
en las terapias intensivas, fundamentalmente debido a la prolongación de la
ventilación mecánica.
El momento preciso de realización y la
indicación, son motivos de controversia, llevando a una decisión
individualizada.
Objetivos: Determinar el timing de traqueostomía en
nuestra terapia, timing respecto pacientes covid o no covid.
Analizar si hubo significación estadística respecto
al tipo de patología que requirió temprana o tardía.
Materiales y métodos: Diseño: Estudios de Corte Transversal
Se revisaron las historias clínicas
electrónicas de 100 pacientes traqueostomizados, en forma percutánea o
quirúrgica, en el periodo enero 2020 a julio 2022 en la unidad de terapia
intensiva de Clinica del Valle. Variables: APACHE, sexo, edad, antecedentes
personales, peso, dias de Ventilación mecánica hasta la realización de
traqueostomía, motivo de ingreso a ARM.
Se definió traqueostomía precoz la realizada
en las primeras 48hs, temprana desde las 48 hs hasta el día 10 y tardía después
de los 10 días de ventilación mecánica.
Las percutáneas fueron realizadas por un
médico intensivista con 1 residente, y las quirúrgicas, por un cirujano.
Análisis estadístico: descriptivo de las
variables cualitativas, frecuencias y porcentajes; las variables cuantitativas
en medias. Se realizó asociación de variables para corroboración de hipótesis
nula.
Resultados: La media de edad fue 63, mayor frecuencia en
hombres 63% vs 37%. APACHE promedio 22. Los antecedentes fueron HTA, DBT y
Obesidad. Las causas de ingreso a ARM fueron: Respiratorias 65 (Covid 28, No
covid 37), Neurológicas 27, Shock 8.
Del total de traqueostomías 3 definieron como
precoces, 21 tempranas y 76 tardías. (Gráfico 1)
En pacientes covid, 27 (96%) fueron tardías,
y no covid, 28 (75%). Respecto a variables relacionadas “Timing de
traqueostomía” y “patología”: en las enfermedades neurológicas predominan las
traqueostomías precoces y tempranas y en las respiratorias, las Tardías.
Resultados en las Pruebas de corroboración de la Hipótesis Nula:
4.2<OR<1.48, CHI7.88, p=0,004995 (IC: 95%) , p=0,004995 (IC: 95%)
(Gráfico 2)
Conclusión: Los resultados del análisis en comparación
con otros estudios entre traqueostomía temprana y tardía son heterogéneos.
Actualmente solo se puede afirmar que el momento más adecuado debe
individualizarse y observar las tendencias a futuro.


0103 Sindrome Antifosfolipidico
Catastrofico, a proposito de un caso
M Cordoba(1), A
Cucci(1), F Morales(1), M Gardeazabal(1), I Parodi(1), C Logiodice(1), J Vilca
Becerra(1), F Fernandez(1), ML Gutiérrez(1), A Paglia(1), L Tumino(1), F
Iglesias(1), C Loudet(1), A Testi(1)
(1) San Martin De La Plata.
Introducción: El síndrome antifosfolipídico catastrófico es
una entidad de muy baja incidencia; 600 casos descriptos al día de la fecha. El
SAF catastrófico es una variante potencialmente mortal que se caracteriza por
múltiples trombosis en corto periodo de tiempo.
Presentación del caso: Paciente de 38 años cursando en el 15° día de
puerperio de su tercera gesta; presenta evento isquémico cerebral con paresia
facio braquio crural derecha, afasia de expresión además ascitis. En la
tomografía computada TC se evidencia infartos pulmonares bilaterales, trombosis
isquémica hepática, trombosis esplénica, isquemia renal izquierda, isquemia de
hemisferio cerebral izquierdo. En el ecodoppler se evidencia: trombosis portal,
esplénica, mesentérica y suprahepática además por TVP infra patelar y trombosis
arterial en MMI.
Se solicitan anticuerpos reumatológicos y
antifosfolipídicos; por alta sospecha de SAF se indicaron tres pulsos de
metilprednisolona, inmunoglobulina IV 400 mg/kg por 5 días, Enoxaparina 60 mg cada
12 hrs.
Evoluciona con deterioro neurológico Glasgow
11/15 (M6 O4 V1) y áreas hipodensas múltiples en la TC de encéfalo, sugestivas
de infarto subagudo, los ANA y AAF fueron negativos en dos determinaciones
durante el episodio agudo (Inhibidor lúpico, anticardiolipinas IgG e IgM y
anti- β2 GP1 IgG e IgM).
Se solicita derivación a nuestro nosocomio por requerimiento de plasmaféresis.
24 horas posteriores a su ingreso evoluciona
con deterioro del sensorio GCS 7/15 con requerimiento de ARM, en la TC donde se
evidencia áreas de isquemia en territorio de arteria cerebral media con
compresión de ventrículos laterales, desviación de línea media > a 5mm por
lo que se decide craniectomía descompresiva.
Al 8° día de internación evoluciona con altos
requerimientos de vasopresores, pupilas midriáticas arreactivas, shock
refractario a tratamiento, falla multiorgánica y muerte
Discusión: La negatividad a los anticuerpos clásicos no
excluye a otros anticuerpos; por lo tanto, el diagnostico de SAF seronegativo
es de exclusión, siendo esencial la sospecha para iniciar un plan terapéutico
temprano y así reducir recurrencias trombóticas y mortalidad.
Conclusión: La sospecha diagnóstica de SAF catastrófico
seronegativo frente a otros tipos de microangiopatías presenta un reto; y más
aún por la evolución rápida y potencialmente mortal.
0104 Complejidad de Presión
Intracraneana como subrogante de Complacencia Cerebral
N Ciarrocchi(1), C
Videla(1), S Hem(1), MDC Garcia(1), F Goldenberg(2), A Mansour(2), C Lazaridis(2),
F Pose(1), F Redelico(1)
(1) Hospital Italiano De Buenos Aires. (2)
Universidad De Chicago.
Introducción: El monitoreo de la presión intracraneana
(PIC) es el principal neuromonitoreo utilizado actualmente, sin embargo su uso
no ha mostrado diferencias significativas en pacientes con trauma de cráneo y
su valores umbrales para el tratamiento siguen siendo tema de debate. El
análisis de complejidad estadística de la onda de PIC, ha mostrado que los
eventos de hipertensión intracraneana (HI) están relacionados con pérdida de
complejidad estadística. Se propone estudiar los cambios en la complejidad
estadística de la onda PIC y su correlación con la complacencia cerebral (CC)
en un modelo experimental de HI.
Métodos: Se desarrolló un modelo porcino de HI
reversible mediante la inserción de una sonda Foley intraparenquimatoso que fue
insuflada con solución salina mediante una bomba de infusión continua. Se
realizo monitoreo de diferentes variables fisiológicas incluyendo la presión
intracreberal (PIC), la presión tisular de oxigeno y el Electoencefalograma Se
descargaron los datos para su análisis posterior.
La complejidad estadística se determinó
mediante la Entropia Wavelet (WE). La CC se definió como el cambio del volumen
intracraneal dividido por el cambio en la PIC. Se contabilizaron los tiempos
entre el inflado del balón y cambio de la WE (Delta Balón) y el ascenso de la
PIC a 20 mmHg (Delta PIC).
Resultados: Se analizaron un total de 15 eventos de HI,
derivados de 4 experimentos. En la tabla 1 se pueden observar la correlación
entre la WE y la CC, asi como también el tiempo Delta Balón (DB) y Delta PIC
(DP) de cada evento. Se observó una correlación promedio de 0,84 entre la WE y
la CC, con una correlación máxima de 0,93 y una mínima de 0,63. Por otra parte
se observó que los cambios de la WE precedían los cambios en la PIC. EL DB
promedio fue de 46,03 segundos, con un DP promedio de 200,67 segundos.
Conclusión: La WE presenta una muy buena correlación con
la CC y sus cambios preceden a los cambios significativos de la PIC, por lo que
de confirmarse estos datos, la WE tiene un gran potencial en el neuromonitoreo
como subrogante de la complacencia cerebral y como predictor de eventos de HI.


MM Kaechele(1), M
Arguello(1), R Villalba(1), M Pohlemann(1), D Acosta(1), A Alarcon(1), R
Ostrowski(1), A Carrera(1), S Ribak(1), C Farquharson(1), N Barreto(1)
(1) Madariaga.
Introducción: En las últimas décadas, se ha producido un
incremento de la demanda de camas en las UTI; debido a la creciente poblacional
asociado a la mayor expectativa de vida. Por esta razón nos planteamos
analizar, las características de los pacientes que ingresan a la UTI del
Hospital Madariaga, en cuanto a motivo de ingreso y pronóstico. Utilizando el
score de APACHE II (Acute Physilogy And Chronic Health Evaluation) para
determinar la probabilidad de muerte de los pacientes ingresados. Analizar los
motivos de ingreso de los pacientes internados en la UTI del Hospital Madariaga
y determinar la probabilidad de muerte de acuerdo al APACHE II.
Materiales y Métodos: El diseño es retrospectivo en base a datos
estadísticos. Se incluyeron todos los pacientes adultos mayores de 18 años,
ingresados a la UTI, durante el 2021. Se utilizó el APACHE II que estima la
severidad de la enfermedad aguda y la probabilidad de muerte de los pacientes
admitidos a la UTI. Para el cálculo se utilizó la página
http://www.somiama.org/APACHE2SOMIAMA/.
Resultados: Se ingresaron un total de 437 pacientes, 274
eran de sexo masculino (62.7%) y 163 de sexo femenino (37,3%). El motivo de
ingreso más frecuente fue la Insuficiencia Respiratoria Aguda (42%),
Postoperatorios (13%), Síndrome Neurológico Agudo (12%), Shock (9%), otros
(17%). El 66% de los pacientes tuvieron una probabilidad de muerte entre 10 y
50%, el 26% tuvo una probabilidad de muerte de más del 50%, y en el 8% la
probabilidad de muerte fue menor al 10%. Los pacientes menores de 30 años
tuvieron una probabilidad de muerte menor del 50%, con un aumento progresivo de
la misma a mayor edad, con predominio en el sexo masculinos
Discusión: Durante el período analizado se observó que
el motivo de ingreso más frecuente a la UTI del Hospital Madariaga fue la
insuficiencia respiratoria. La probabilidad de muerte, calculada con el APACHE
II fue, entre el 10 y el 50% , con un mayor riesgo en el sexo masculinos con un
incremento progresivo en función de la edad.


0107 TERAPIA DE ALTO FLUJO EN
TRAQUEOSTOMÍA COMO ESTRATEGIA EN DESTETE PROLONGADO: REPORTE DE CASO
AE Gomez, JI
Fernandez(1), O Reniero(1), ME Dure(1)
(1) Instituto De Cardiologia De Corrientes.
Introducción: La asistencia ventilatoria mecánica (AVM)
prolongada afronta la búsqueda de nuevas estrategias que permitan acortar su
tiempo de uso en pos de disminuir la estancia hospitalaria y la aparición de
complicaciones que comprometan aún más el estado funcional del paciente 1. El
efecto de la terapia de alto flujo en traqueostomizados ha demostrado mejoría
de la oxigenación, sin favorecer trabajo respiratorio 2,3,4.5.
Caso clínico: Paciente femenina, 49 años, IMC de 16.88,
desnutrición severa, insuficiencia cardíaca avanzada con reemplazo valvular aórtico,
complicaciones cardíacas y respiratorias, AMV prolongada, traqueostomía
quirúrgica a los 21 días. Luego de intentos fallidos de destete por taquipnea y
disnea, al mes se realizó la primera desconexión sin progresión en tiempo
durante las dos semanas siguientes. Se observaba ansiedad y dependencia al
soporte ventilatorio. Durante ocho días se utilizó terapia de alto flujo a
través del sistema Airvo Fisher & Paikel empleando el conector swivel
(figura 1), incrementando el tiempo de uso con reconexiones en ventilación
controlada por presión, hasta alcanzar 24 horas diarias (tabla 1). En 72 horas
posteriores, se logró la desvinculación exitosa al séptimo día respirando a
través de vía aérea natural después de más de dos meses en AMV, con la
consiguiente decanulación. Se continuó con entrenamiento muscular y
respiratorio.
Discusión: El presente caso destaca la terapia de alto
flujo traqueal como estrategia durante el destete prolongado 6. Sólo se
realizaron reportes de casos en pacientes con patologías restrictivas y con
Covid 7.8. Se conoce el efecto de esta terapia por vía nasal, en comparación a
la aplicada a través de una traqueostomía que no es capaz de generar el mismo
nivel de presión en la vía aérea pero con un flujo inspiratorio administrado
que podría disminuir la presión negativa que se debe generar durante la
inspiración 3. Además, permite una humidificación superior al oxígeno
convencional, pudiendo proveer un adecuado soporte respiratorio y como una
alternativa de mejor tolerancia 5,9.
Conclusión: La administración de terapia de alto flujo a
través de traqueostomía fue beneficiosa como estrategia durante el destete de
la ventilación mecánica prolongada.


0108 TEAM Covid en pandemia por
Sars-Cov 2
D Duarte(1), G Benavent(1),
A Monson(1), D Espinel(1), Y Escobar(1), E Sanchez(1), M Maidana(1), R
Sanabria(1), J Roldan(1), N Raimondi(1)
(1) Cemep.
Objetivo: Determinar la epidemiolgia y mortalidad en
pacientes con covid en una institución privada no Covid.
Materiales y métodos: Estudio retrospectivo observacional,
descriptivo y analitico. Fueron incluidos todos los pacientes admitidos AC
según la definicion del Ministerio de Salud de la Provincia ( casos sospechoso,
diagnostico clinico, PCR), desde el periodo comprendido entre 27 de Julio 2020
al 27 diciembre 2020, se realizo TAC Torax, gasometria arterial, LDH, Ac
lactico. Se registraron las siguientes variables: Edad, sexo, conmorbolidades
(C), días de comienzo de
sintomas(CS) ,SAPS II, APACHE II, Indice de gravedad covid (IGC) (Relac N/L x
dimero D x PCR / 10.000), PAM, Frecuencia cardiaca (FC),Relleno capilar (RC),
dosis de noradrenalina (NADR), dobutamina (DB), balance de liquidos 24 hs.
(BL), lactato (L),SvcO2, Intubacion orotraqueal ( IOT), Canula de Alto Flujo de
O2 ( CAFO), Ventilacion Prono (VP), Delta Presion (DP), PAFI,PEEP,Germenes
prevalentes intrahospitalario (GPI), Reemplazo renal, mortalidad. El team de
covid valoraba los 10 signos de vitalidad y el IGC luego implementaba el protocolo de actuacion con objetivos en 1 hora.
Se realizó análisis estadístico utilizando la media, el desvío estándar y el
test Fischer para las variables cuantitativas y el Chi cuadrado para las
variables dicotómicas, considerando como significativo una probabilidad de
error menor de 5% (*p< 0.05). Se realizo analisis bivariado y multivariado
de regresion logistica.
Resultados: Se evaluaron 176 pacientes (p) que ingrearon
AC, la edad promedio 53+/- 16 años, la media de SAPS II 54, la media de APACHEII
12, las C mas prevalentes (DBT 37.5%, obesidad 35%),la media de CS 8 días (3-16
días) . Los dias de ventilacion mecanica invasiva fueron 17 dias (5-29), la
media de estancia en el STI fue de 22 (6-45), requirieron 17 % de reemplazo
renal, la mortalidad global fue del 16.4 (29 p) %.GPI ( Ps panresistente, Kleb
BLEE, Acinetobacter sp,Stafilo sp, Clostridium Sp) En el analisis bivariado de
supervivencia se encontraron diferencias estadisticamente significativa entre
sobrevivientes(S) y no sobrevivientes ( NS) en las variables
Edad,CS,PAFI,FC,RC.
Conclusión: Los pacientes con Sars - Cov 2, la mortalidad
estuvo relacionado con la edad, dias de evolucion de la enfermedad y relleno
capilar deficiente.
0109 SEPSIS A SERRATIA
MARCESCENS EN CIRUGIA PROGRAMADA (presentación de caso clínico)
ME Olobardi(1), N
Moscillo(1), L Iwanczyna(1), A Fernandez(1), AM Mazzola(1)
(1) San Felipe.
Introducción: La S. marcescens es un bacilo Gram negativo
de la Familia Enterobacteriaceae que puede encontrarse en la flora intestinal
del hombre y animales, en el ambiente, reservorios pobres en nutrientes como el
agua potable, cañerías, llaves; así como también en insumos hospitalarios como
jabones, antisépticos, etc. Su adquisición es mayoritariamente nosocomial,
especialmente en unidades de cuidados intensivos, siendo secreciones
respiratorias, heridas y orina, sitios frecuentes de colonización.. La
mortalidad asociada a este agente oscila entre 25 y 30%.
Presentación del caso: paciente de 41 años de edad, se realiza cirugía
programada de hemitiroidectomia por nódulo tiroideo bethesda II, complicada con
hemorragia realizándose hemostasia intraquirugica. Evoluciona a las 48 horas
con disnea, taquicardia , oliguria e ictericia; laboratorio con disfunción
orgánica múltiple (con trastorno de la coagulación, renal y hepática). Requiere
soporte médico en unidad de cuidados críticos y hemodiálisis. Se aísla en
cultivo de herida quirúrgica Serratia Marcenses. Se realiza tratamiento
antibiótico efectivo con buena evolución, logra externarse al mes de su
ingreso.
Discusión: Infección por S. marcescens . Sepsis Severa
de rápida evolución. Brote intranosocomial.
Conclusión: Existen reportes de brotes epidémicos de S.
marcescens que señalan como potenciales fuentes de transmisión los equipos de
ventilación mecánica, desinfectantes, jabones y manos, otorgándose un rol
fundamental en su origen al quiebre de la técnica aséptica, la reducción en la
frecuencia en el lavado de manos y el incumplimiento de las normas destinadas
al control de infecciones nosocomiales. Se logro detectar un brote
intranosocomial por S. marcescens a raíz de un caso clínico de sepsis severa en
cirugía programada. Luego de este caso clínico ingresaron pacientes con similar
presentación clínica y mismo aislamiento bacteriológico. Es importante realizar
una detección temprana para intervenir oportunamente y evitar la propagación de
casos.
0110 ENFERMEDAD NEUROMUSCULAR
AGUDA: CRISIS MIASTÉNICA. REPORTE DE DOS CASOS
MS Fachinat(1), V
Leiva(1), M Franco(1), D Villani(1), L Leit(1), E Matijacevich(1), M Marino(1),
C Lattanzio(1), R Rodriguez(1), M Fuente(1), R Visintin(1), J Lassaga(1), B
Jimena(1)
(1) Higa San Jose Pergamino.
Introducción: La Miastenia Gravis es una enfermedad
neuromuscular autoinmune con una incidencia de 10/1.000.000. Se presenta con
debilidad general o localizada de proximal a distal que incrementa con el
ejercicio y el día. Puede desencadenarse por infecciones o el uso de fármacos.
El diagnóstico se basa en la clínica, y la presencia de los anticuerpos, que
son sensibles y específicos. Sin embargo, existe un subgrupo 15% negativo.
Caso 1: Femenina de 23 años. Presenta debilidad
progresiva céfalo caudal de 24 hs, agrega disfagia, sialorrea, perdida del
sostén cefálico y abolición de los reflejos tendinosos. Evoluciona con
insuficiencia ventilatoria y requerimiento de ARM. Se toman muestras para
serologías, búsqueda de anticuerpos, cultivos, inicia empírico Ceftriaxona y
Aciclovir. TAC y RMN. Inmunoglobulina EV y bromuro de piridostigmina con mejoría
clínica.
Caso 2: Femenina de 15 años con ptosis palpebral,
estrabismo convergente, disfagia, sialorrea, y fatiga generalizada más
hiporreflexia tendinosa de 72 hs, con requerimiento de ARM por insuficiencia
respiratoria. Se toman muestras para serologías, y búsqueda de anticuerpos. TAC
y RMN. Inicia inmunoglobulina EV y bromuro de piridostigmina, con mejoría
clínica.
Discusión: diagnósticos diferenciales con botulismo,
síndrome de Guillain-Barré, Lambert-Eaton, ELA, Esclerosis múltiple, y timoma.
En ambos casos las RMN, los anticuerpos y los cultivos fueron negativos, sin
embargo, evolucionaron favorablemente posterior al inicio del tratamiento con
inmunoglobulina EV y de bromuro de piridostigmina, recuperando movilidad y
fuerza de forma gradual, permitiendo, la progresión del weaning y pase a sala.
Conclusión: El 20% de pacientes sin diagnóstico, debuta
con crisis miasténica. La sospecha clínica, el examen neurológico, y el
monitoreo respiratorio son importantes, ya que el ingreso a UTI es por falla respiratoria,
la estadía promedio es de tres semanas, y la mortalidad del 5-19%. Las crisis
son reversibles con fármacos inhibidores de la acetilcolinesterasa e
inmunoterapia.

N Ciarrocchi(1), C
Videla(1), F Pose(1), S Hem(1), MDC Garcia(1), F Goldenberg(2), A Mansour(2), N
Issa(2), C Lazaridis(2), F Redelico(1)
(1) Hospital Italiano De Buenos Aires. (2)
Universidad De Chicago.
Introducción: El Electroencefalograma (EEG) es método no
invasivo de monitoreo de la actividad eléctrica cerebral. Se conoce que el EEG
presenta cambios dinámicos secundarios flujo sanguíneo (FSC) cerebral. Por lo
tanto, es plausible considerar que el EEG presenta cambios característicos de
isquemia cerebral secundaria a alteraciones en el FSC en el contexto de
hipertensión intracraneal (HI). Se propone estudiar dicha relación en un modelo
porcino.
Métodos: Se desarrolló un modelo porcino de hipertensión
intracraneana (HI) mediante la inserción de una sonda Foley dentro del
parénquima cerebral que fue insuflada con solución salina mediante una bomba de
infusión continua. Durante el experimento se realizó monitoreo de diferentes
variables fisiológicas incluyendo la presión intracerebral (PIC), la presión
tisular de oxigeno (pTo2) y el EEG.
El EEG se descompuso en 5 sub-bandas según su
frecuencia, es decir, alfa (8-13 Hz), beta (14-30 Hz), delta (<4 Hz), gamma
(>30 Hz) y theta (4-7 Hz). Hz) y todas las estadísticas se estimaron sobre
cada una de las sub-bandas filtradas utilizando ventanas rectangulares
deslizantes de 3 segundos (900 muestras) y un desplazamiento de 1 segundo (300
muestras) entre un par de ellas.
Resultados: Se analizaron 12 eventos de IH,
correspondientes a 3 experimentos de los realizados. En la figura 1, se
observan 4 eventos de unos de los experimentos analizados. Se observó una
diferencia significativa en la potencial total del EEG durante los eventos de HI
(24040.41 ± 5060 vs. 14369.61 ± 5169.04, p 0.0014). En el análisis de sub
bandas se observaron cambios estadísticamente significativos en sub-banda delta
durante los eventos de HI (16702.80 ± 3031 vs 10023.28 ± 3572.98, p 0,0005) y
en la sub-banda theta (4456.59 ± 2185.38 vs 2290.39 ± 1328.78). Se observo
durante todo el experimento la potencia relativa del EEG de la banda delta fue
la principal con un promedio de 69.21% seguida de la sub-banda Theta con
promedio de 19.04%, sin diferencias significativas durante los eventos de IH.
Conclusión: El EEG muestra cambios significativos durante
los eventos de IH que pueden ser cuantificados. El EEG es una herramienta con
potencial utilidad para el neuromonitoreo de pacientes con riesgo de HI.

0112 Síndrome de aorta media,
excepcional causa de emergencia hipertensiva en adultos
S Gasparotti(1), LM
Rodriguez(1), FP Bertoletti(1), S Calegaris
(1) Clinica San Jorge.
Introducción: El síndrome de aorta media (SAM) se define
como un estrechamiento segmentario de la porción toraco-abdominal de dicha
arteria y de las ramas que de ella derivan, con predominio de afección renal.
Es una entidad clínica infrecuente (0,5-2% de
la población general) y excepcional en la población adulta.
La presentación clínica es la hipertensión
arterial de difícil manejo, generalmente renovascular e injuria renal.
Presentación del caso: Paciente femenina de 69 años con antecedentes
de HTA. Medicada con losartán 100 mg e hidroclorotiazida 12.5 mg.
Ingresa por emergencia hipertensiva asociada
a edema agudo de pulmón e injuria renal aguda. Se destaca diferente valor de
tensión arterial entre miembros superiores e inferiores. Requiere tratamiento
antihipertensivo escalonado, hemodiálisis y soporte ventilatorio.
Se realizó angiotomografía que evidencia stop
en aorta abdominal suprarrenal con ausencia de flujo distal y gran desarrollo
de circulación colateral periférica; y arteriografía renal con oclusión total
de arteria renal derecha y relleno por colaterales de arteria renal izquierda.
Evoluciona tórpidamente, con HTA refractaria
por lo que se realizó nefrectomía izquierda asumiendo riñón hiperreninémico. y
posteriormente bypass extra anatómico subclavio-bifemoral con lo que se logra
mejoría clínica.
Discusión: El SAM se vincula principalmente con la
enfermedad de Takayasu, afecta a mujeres en edad temprana. La HTA ocurre en el
70% de los pacientes, asociada generalmente a estenosis en la arteria renal o
arteriosclerosis. Su tratamiento es médico y eventualmente quirúrgico, el bypass
extra anatómico puede ser beneficioso en aquellos pacientes que no son
candidatos a resolución endovascular.
La causa renovascular hay que sospecharla en
HTA refractaria asociada a edema agudo de pulmón, rubicundez e injuria renal
aguda. En este caso, la nefrectomía es la última instancia terapéutica.
Conclusión:
En la emergencia
hipertensiva refractaria es crucial el diagnóstico etiológico, dentro de estos
la patología renovascular. Se debe evaluar mediante estudios complementarios
que evidencien el hipoflujo renal como etiología y entre ellos el SAM. El
tratamiento habitual de la estenosis renal es endovascular, el cual no fue
viable en nuestra paciente dada su malformación congénita.

A Senger(1), R
Benitez(1), S Amelia(1), S Altemburger(1)
(1) Materno Neonatal.
El objetivo fue describir el manejo y
resultados de mujeres embarazadas y puérperas con coronavirus dentro de la
unidad de terapia obstétrica.
Material y métodos: Estudio retrospectivo y observacional en el
que se incluyeron todas las usuarias con PCR positiva para sars-cov 2
ingresadas a la Unidad de Cuidados Críticos Obstétricos en un Hospital Público
Materno Neonatal de la Provincia de Misiones desde el 01/01/2021 al 31/12/2021.
Resultados: Se identificaron 35 usuarias, la media de
edad fue de 30 años. El 60% (21) ingresaron embarazadas, con una media de edad
gestacional de 26 semanas. El 40% (14) fueron postoperatorios de urgencia, con
edad de nacimiento de 33 semanas. El 100% de las mujeres tuvieron un esquema de
tratamiento de: corticoides, enoxaparina, ceftriaxona, azitromicina; el 45%
recibió ivermectina y el 16% ibuprofenato de sodio. El promedio de la estancia
de internación fue: 14 días. El 16% (5) decúbito prono, de las cuales 4 estaban
embarazadas. El 51% (18) AVM, con una duración media de 12 días . El 23% (8) CPAP
y el 26% (9) utilizaron otros dispositivos. El 11% (4) no sobrevivieron al
tratamiento, 2 eran embarazadas pretérminos de 35 semanas de gestación que
dieron a luz durante la instancia en la UTIO, 1 embarazada de 22 semanas y 1
aborto de 12 semanas. Las mujeres tenían una puntuación mediana de evaluación
secuencial de Falla Orgánica (SOFA) de 5 puntos y una mediana de Evaluación
Fisiológica Aguda y Evaluación de Salud Crónica II ( APACHE II) de 17 puntos al
ingreso. 2 mujeres se encontraban vacunadas con una dosis. Durante la
internación todos los partos ocurrieron prematuros con una media de 33 semanas
de edad gestacional.
Conclusión: Como
resultado una buena supervivencia materna en la UTIO y un parto pretérmino
moderado. Ciertamente se puede intentar la continuación del embarazo durante la
ventilación mecánica y la posición prona con un buen monitoreo fetal. Las
mujeres que fueron postoperatorias presentaron un mayor deterioro respiratorio
en la ventilación mecánica, que las usuarias embarazadas.
0115 COLAPSO SUBGLÓTICO
TRAQUEAL SUPRAOSTOMÍA COMO FALLA EN EL PROCESO DE DECANULACIÓN
G Chiappero(1), A
Falduti(1), ME Catini(1)
(1) Fernández.
Introducción: El colapso supraostomía (CSO) es una
complicación descripta en pediatría en pacientes con traqueostomía de larga
duración, que de acuerdo con la magnitud del colapso puede interferir con la
decanulación.
Objetivos: Reportar el CSO como hallazgo infrecuente en
adultos, describir sus características diferenciales y las estrategias
diagnósticas y terapéuticas implementadas.
Material y métodos: Serie de casos retrospectiva de pacientes
traqueostomizados, con CSO y falla en el proceso de decanulación.
En nuestra unidad se realiza de forma
rutinaria la evaluación endoscópica de la deglución y de la vía aérea antes de
la decanulación, con el objeto de valorar la presencia de disfagia y para
descartar otras patologías relacionadas con la traqueostomía.
Para describir el CSO adoptamos el sistema de
clasificación propuesto por Antón-Pacheco, que lo clasifica de acuerdo con el
porcentaje de obstrucción observado: moderado entre 50-75% y severo >75% de
obstrucción de la luz traqueal
Resultados: Cinco pacientes mostraron CSO, durante ese
mismo período (marzo 2020 - diciembre 2021) fueron evaluados 83 pacientes. Los
datos recopilados se muestran en la tabla 1.
Se observó colapso moderado en 2 y severo en
3 pacientes
En cuatro pacientes se implementó ventilación
a fuga como estrategia terapéutica, en uno fue necesario colocar un Montgomery
y uno requirió cánula de Biesalsky por su condición clínica. La decanulación
definitiva se logó en todos los pacientes.
Discusión: El CSO se refiere al colapso anormal de la
pared traqueal por encima de la ostomía que conduce a una obstrucción dinámica
de las vías respiratorias durante la espiración.
Aunque endoscópicamente se puede observar
como una obstrucción de la luz traqueal casi completa, generalmente no es una
estenosis fija. El colapso dinámico de las estructuras traqueales se manifiesta
como un contacto entre las paredes anterior y posterior (figura). A diferencia
de lo reportado en pediatría la obstrucción observada fue a expensas de la
pared posterior.
Conclusión: El examen endoscópico es fundamental para el
diagnóstico de CSO.
La ventilación a fuga como método de
estabilización neumática de la tráquea y rehabilitación de la vía aérea
superior, permitió completar el proceso de decanulación en cuatro pacientes.


0116 NEUMONÍA AGUDA DE LA
COMUNIDAD POR STENOTROPHOMONA MALTOPHILA. REPORTE DE UN CASO CLÍNICO
F Cometto, M
Jaime(1), O De Nardis(1), HA Trillard(1), M Binci Vayer(2), S Dipente(2), E
Guzman(1), G Martinez(1), M Ciarlantini(2)
(1) Sanatorio Aconcagua. (2) Hospital Militar
Regional Córdoba.
La Stenotrophomona maltophilia es un bacilo gramnegativo
multirresistente, se comporta como patógeno oportunista, particularmente entre
los pacientes hospitalizados. Está asociado con una alta morbimortalidad en
individuos gravemente inmunocomprometidos y debilitados. Los factores de riesgo
incluyen enfermedades respiratorias crónicas, neoplasias hematológicas,
neutropenia inducida por quimioterapia, trasplante de órganos, infección por el
virus de la inmunodeficiencia humana y pacientes en hemodiálisis.
Paciente de sexo femenino de 69 años con
antecedentes de obesidad mórbida, EPOC y tabaquismo consulta por tos con
expectoración purulenta y hemoptisis de una semana de evolución acompañado de
disnea y fiebre. Progresa con desaturación de 75% a aire ambiente, mala
mecánica ventilatoria e hipotensión arterial requiriendo ingreso a Terapia
Intensiva, se intuba y conecta a asistencia respiratoria mecánica. Ante
sospecha de neumonía grave de la comunidad se cultiva, con muestra de aspirado
traqueal para gérmenes comunes y BAAR e inicia tratamiento empírico con
ampicilina-sulbactam.
Laboratorio de ingreso (tabla 1). Persiste
con fiebre y altos requerimiento de oxígeno, se solicita perfil reumatológico,
serología viral y marcadores tumorales con resultado negativos. Se recibe
informe de aspirado traqueal con desarrollo de Staphylococcus aureus MS y
Stenotrophomona maltophila sensible a trimetoprima sulfametoxazol. Se rota
antibioticoterapia según sensibilidad. con buena respuesta. Persiste con
miopatía y destete dificultoso, requiriendo traqueostomía quirúrgica al día 15
de ARM. Posteriormente progresa con buena respuesta y mejor tolerancia a
pruebas de ventilación espontánea logrando destete el día 29° de internación.
El dia 40° es externada, decanulada y con aporte de oxígeno en domicilio.
Es crucial diferenciar entre la colonización
no invasiva de muestras no estériles y una infección real que amerita
tratamiento. Es preciso tener en cuenta la S. maltophilia en neumonías severas.
Los tratamientos de combinación antibiótica en los pacientes inmunocomprometidos
no cubren rutinariamente a esta bacteria, por lo que es importante hacer un
esfuerzo para identificarla en esa población, así como en los pacientes con
fibrosis quística, pulmonares crónicos y en los todavía esporádicos casos de
infecciones comunitarias.

0117 REPORTE DE CASO, MIELITIS
TRANSVERSA VS TRAUMA MEDULAR
NM Valenzuela(1), MG
Lafuente(1), MA Acuña(1)
(1) Hospital De Pediatría Dr Fernando
Barreyro.
Introducción: La mielitis transversa (MT) es una patología
medular inflamatoria caracterizada por disfunción aguda o subaguda motora,
sensitiva y autonómica. La incidencia es baja, habiéndose comunicado la
mayoría, en pacientes inmunocomprometidos. Presentamos un caso de un paciente
inmunocompetente con antecedente solapado de trauma medular.
Presentación del caso: Paciente masculino de 3 años, con diagnostico
de mastocitosis, en tratamiento. Actualmente consulta por 24hs de traumatismo
al caer de una cama elástica mientras jugaba, presentando inmediatamente
alteración en la marcha que pasa desapercibida. Horas posteriores por registro
subfebril recibe paracetamol y notan inmovilidad de miembros inferiores, e
inestabilidad a la sedestación por lo que consultan y solicitan su derivación.
Al examen físico se encuentra con Glasgow máximo, lesiones pigmentadas por
patología de base, hemiparesia de miembros inferiores, hiperreflexia patelar,
tendencia al equino bilateral, babinski positivo bilateral y edema en ambos
pies con godet +, miembros superiores sin afectación sensitiva o motora evidente,
resto del examen físico normal. Ante la sospecha de Lesión Medular Traumática
(SCIWORA) se difiere realización de Punción Lumbar (PL) y pasa a UCI.
Se indica Corticoide evolucionando en horas
con deterioro hemodinámica y del sensorio ingresando a TIP. Se realiza RNM
(Figura 1) de columna vertebral presentando amplia lesión desmielinizante
tóraco-cervical, sin relación con el antecedente del traumatismo, reasumiéndose
como probable MT. Completa 5 días de corticoide EV, con buena respuesta. Se
Repite RNM (Figura 2), mejorada con respecto a la previa. Esto permite realizar
PL que descarta etiología infecciosa y autoinmune, con serologías virales y
cultivos negativos. Evoluciona favorablemente recibiendo kinesioterapia
neurorehabilitadora.
Discusión: Según literatura revisada, las causas de MT
se limitan a procesos autoinmunes o infecciosos, pero en gran medida no se
logra determinar el origen como ocurrió en este paciente. Tampoco pudimos
encontrar relación a vacunación previa, ni tampoco alteraciones en LCR que
justifique un origen autoinmune. En este caso para el diagnostico las
Neuroimágenes fueron importantes, sin embargo no se pudo determinar etiología.
Conclusión: Consideramos importante este caso clínico ya
que elementos del interrogatorio pudieron sesgar la sospecha diagnostica,
recurriendo ante la duda y evolución a exámenes complementarios que permitieron
definir terapias oportunas.


0118 COVID-19 Y ENCEFALITIS
HERPÉTICA
M Ramirez Colombres,
CE Maenza(1), NS Rocchetti, SP Gattino, S Diodati, C Luchitta, M Re, CJ
Settecase, DH Bagilet
(1) Hospital “Eva Peron”.
Introducción: El virus SARS-CoV-2 perteneciente a la
familia Coronaviridae, causante de la COVID-19, puede en función de lo
observado hasta el momento y por extrapolación del compromiso neurológico de
otros virus de esta familia, generar lesiones a nivel del sistema nervioso. Son
múltiples los estudios en relación a esto, aunque, escasos los asociados a
encefalitis. A la vez, se desconoce el efecto del SARS-CoV-2 sobre la expresión
clínica de otros virus neurotropos, como los pertenecientes a la familia
Herpesviridae.
Casos clínicos: Se describen dos casos de varones jóvenes (39
y 18 años), con detección de SARS-CoV-2 mediante RT-PCR en muestra
nasofaríngea, con diagnóstico clínico y análisis de LCR (líquido
cefalorraquídeo) compatibles con encefalitis, en los que se obtuvo PCR
positivas para virus varicela zoster y herpes simple tipo 1 y 2,
respectivamente. El primer paciente presentó, fiebre, cefalea, vómitos, tos,
conductas inapropiadas y convulsiones, mientras que el segundo fiebre, cefalea,
mialgias y exantema. Ambos presentaron linfopenia y elevación de IL-6. En LCR
se observó pleocitosis con predominio de monomorfonucleares, asociado a
hiperproteinorraquia y glucorraquia normal. La tomografía computarizada de
cráneo evidenció edema cerebral difuso leve en el primer caso, sin alteraciones
en el segundo. En los dos casos se realizó tratamiento con corticoides,
antibióticos y aciclovir. El primero presento mala evolución, mientras que el
segundo fue favorable.
Discusión: Si bien se conoce poco en cuanto a la
asociación de encefalitis y COVID-19, los casos reportados muestran mayor
probabilidad de desarrollo en pacientes gravemente enfermos, de edad avanzada y
con comorbilidades y peor pronóstico en ellos. Aún se desconoce su
fisiopatogenia, pero se considera que podría deberse a lesión viral directa,
inmunomediada o sobreinfección por microorganismos neurotropos, como los virus
de la familia Herpesviridae. Como posibles tratamientos se han propuesto el uso
de corticoides, plasmaféresis, anticuerpos monoclonales y el tratamiento
dirigido a los agentescoinfectantes, sin embargo, se requieren mayores
estudios.
Conclusión: Es importante considerar la encefalitis como
forma de presentación de la COVID-19 y la posible coinfección con Herpesvirus,a
fin de realizar un diagnóstico precoz y tratamiento oportuno que mejore el
pronóstico.
0119 ESOFAGO NEGRO EN PACIENTE
CON POLITRAUMA Y SHOCK HIPOVOLEMICO
EJ Gironacci(1), A
Bianchi(1), MN Göldy(1), N Ortiz(1), E Gonzalez(2), I Gustavo(1), L
Talamonti(1), SI Sanchez(1), E Gonzalo(1)
(1) Hospital Provincial De Rosario. (2)
Hospital Provincial De Rosario.
Introducción: Es una rara entidad que se diagnostica por endoscopia
y se reconoce por el aspecto negro difuso. Su origen es multicausal, el
compromiso isquémico es el factor fisiopatológico fundamental. Puede extenderse
a lo largo de todo el esófago. Presentamos el caso de un paciente con dicho
diagnóstico interpretado en el contexto de hipoperfusión por shock hipovolémico
con evolución favorable y reepitelización ad integrum.
Presentación del caso: Masculino de 51 años, obeso, diabético tipo
II, hipertenso,dislipémico que ingresa a cuidados criticos en post operatorio
inmediato de esplenectomia con abdomen abierto y contenido por hematoma
esplénico secundario a politrauma, evoluciona con shock hipovolemico y
requerimiento de vasoactivos. Intercurre con esofago negro que se presenta con
hematemesis resolviendo ad integrum. También presenta múltiples complicaciones:
infecciones intrahospitalarias, evisceración y ARM prolongado que requiere
traqueostomía. Evoluciona favorablemente y se da de alta.
Discusión: El hallazgo de necrosis esofágica aguda es
muy raro, como también sus diagnósticos diferenciales incluyendo el melanoma
maligno, acantosis nigricans, pseudomelanosis, ingesta de cáusticos y
melanocitosis del esófago . El tratamiento se basa en la reanimación y
corrección de las patologías de base
La frecuencia encontrada en necropsias es
entre 0 y 10,3% en contraste con los reportes endoscópicos que oscila entre
0,01% y 0,2%. Por lo cual se estima que esta patología es subdiagnosticada.
La mortalidad reportada oscila entre el 33 y
el 50%, la mayoría de las muertes fueron causadas por enfermedad de base y no
son atribuibles a la enfermedad en sí. Dentro de las complicaciones, la
principal es la estenosis del esófago que puede ocurrir en aproximadamente el
15% de pacientes y la perforación que oscila en un 7%.
Conclusión: Si bien el esófago negro no es diagnosticado
frencuentemente, representa una causa potencialmente mortal en los pacientes
con shock, de alli la importancia de sospecharlo en pacientes críticos con
signos de hipoperfusión.


0120 ENFERMEDAD POR ANTICUERPOS
ANTIMEMBRANA BASAL GLOMERULAR EN PACIENTE CON COVID-19
M Ramirez Colombres,
CE Maenza(1), M Latimori, F Garavelli, F Dipaolo, M Re, SP Gattino, NS
Rocchetti, CJ Settecase, DH Bagilet
(1) Hospital “Eva Peron”.
Introducción: La enfermedad por anticuerpos antimembrana
basal glomerular (anti-MBG) es un trastorno autoinmune poco frecuente,
caracterizado por hemorragia alveolar difusa (HAD) y glomerulonefritis
rápidamente progresiva (GNRP) en relación a anticuerpos contra la cadena alfa-3
del colágeno de tipo IV. La COVID-19 ha sido señalada como desencadenante de
este trastorno.
Caso clínico: Mujer de 27 años con antecedente de
epilepsia, sin vacunas para COVID-19, consulta por cuadro de dos semanas de
disnea progresiva, vómitos alimentarios y diarrea acuosa. Ingresa a Unidad de
Cuidados Intensivos por insuficiencia respiratoria. Al examen físico: FC 120
lpm, FR 38 rpm, TA 180/110 mmHg, Tº38°C, SatO2 88% (mascara reservorio), PVC 12
cmH2O. Somnolienta, sin focalidad neurológica; rales crepitantes mediobasales
bilaterales; edema infrapatelar. APACHE 22; SOFA 9. Laboratorio: Hto 18%, Hb
6,1 g/dl (VCM 83fl, HCM 28,2pg, CHCM 34,1 g/dl, ADE 12,9%, ferremia 41µg%,
ferritina 178µg/l, saturación de transferrina 16%, TIBC 184µg/dl, haptoglobina
50 mg%), leucocitos 12700/mm3, linfocitos 930/mm3, urea 207mg%, creatinina
16,35mg%, potasio 6,5mEq/l, calcio 4,6 mg/dl, fosforo 8 mg/dl, proteínas 5,8
g/dl, albumina 2,6 g/dl.pH 7,33, pO2 102mmHg, pCO2 22mmHg, HCO3 11,3mEq/L, EB
13,4, Sat 97,9%. Orina: hematíes y hemoglobina tres cruces, cilindros
hemáticos, hematíes dismórficos 25%, relación proteinuria/creatininuria 1920
mg/g, FeNa 3,43%. Serologías para VIH, VHB, VHC, VDRL, dengue, leptospirosis y
hantavirus negativas; proteinograma por electroforesis, IgM, IgG, IgA, IgE,
FAN, FR, C3, C4, ANCA C y P normales. Anticuerpos anti-MBG positivos. ECG: T
amplitud aumentada. Radiografía de tórax: infiltrados heterogéneos en cuatro
cuadrantes. Ecografía abdominal y transvaginal sin alteraciones. Hemocultivos y
urocultivo negativos. Requirió AVM con parámetros de SDRA (PaFiO2102). Realizó
ciclofosfamida, pulso de corticoides y plasmaféresis. Presentó mala evolución y
falleció a las 24 Hs.
Discusión: Se considera que la COVID-19 podría generar
lesión endotelial pulmonar, exposición de epítopes de la membrana basal
alveolar y generación de anticuerpos contra los mismos, manifestándose como HAD
y GNRP. Presenta un pronóstico desfavorable y alta morbimortalidad.
Conclusión: La COVID-19 y las alteraciones inmunológicas
que conlleva, contribuiría a la presentación de estas patologías inmunomediadas
menos frecuentes, haciendo indispensable una alta sospecha y tratamiento precoz
a fin de mejorar la morbimortalidad.
0121 LA INSUFICIENCIA CARDÍACA
AGUDA COMO MANIFESTACIÓN DE LA TIROTOXICOSIS: A PROPÓSITO DE UN CASO
MG Montenegro
Fernandez(1), CJ Beroiza(1), MM Cruz(1), LG Duran(1), NA Grassi(1), AV
Millàn(1), M Petasny(1), NI Zelaya De Leon(1), P Zorzano(1)
(1) Municipal Dr. Leónidas Lucero.
Introducción: La tormenta tiroidea o tirotoxicosis se
considera una emergencia endocrinológica; suele ser la complicación más grave y
menos frecuente de una patología relativamente frecuente como es el
hipertiroidismo. Tiene afectación a nivel sistémico, con especial hincapié en
el sistema cardiovascular, por lo que una de las manifestaciones más
prevalentes y a considerar en este trabajo, es la insuficiencia cardiaca aguda.
Desarrollo del caso clínico: Paciente femenina de 40 años con antecedente
de tabaquismo e hipertiroidismo diagnosticado hace 10 años, con abandono de
medicación (metimazol) y de controles en contexto de pandemia. Refirió haber
consultado en reiteradas ocasiones en otro centro asistencial por evento
sincopal asociado a palpitaciones, agregando en esta última consulta episodio
de tos con expectoración hemoptoica y nauseas. Laboratorio con TSH <
0.01mU/L y T4 7.77 pmol/L.Troponinas 19.3 ng/L. Evolucionó con hipotensión sin
respuesta a cristaloides y mayor disnea, por lo que se realizó intubación orotraqueal.
Se realizó ecocardiograma que informaba función sistólica con deterioro severo
(FEY 30%). Realizó tratamiento con metimazol y solución de Lugol con mejoría de
los parámetros de laboratorio. A los diez intercurre con abdomen agudo
perforado que evoluciona shock séptico refractario y fallece.
Discusión: Luego de examinar la bibliografía disponible,
y contrastarla de forma retrospectiva con la evolución de la paciente, se puede
demostrar la relación entre hipertiroidismo y los cambios hemodinámicos.
Conclusión: En el caso presentado, la paciente tuvo como
antecedente el diagnóstico de hipertiroidismo, y se consideró que el factor
desencadenante fue la suspensión del metimazol; a su vez, la insuficiencia
cardíaca aguda que presentó durante los primeros días de internación fue
consecuencia del efecto cardiovascular directo de las hormonas tiroideas, como
son la tiroxina (T4) y la triyodotironina (T3), esta última teniendo mayor
relevancia.
V Bas(1), M Jofre(1)
(1) Hospital Italiano.
Introducción: Los pacientes ingresados en unidades de
cuidados intensivos pediátricos (UCIP) tienen mayor probabilidad de verse
afectados por errores a medicamentos, los cuales pueden ser prevenibles. Estos
pueden deberse a diversos factores: mayor carga de trabajo del personal,
características de los medicamentos que se utilizan, funciones fisiológicas
alteradas, complejidad y gravedad.
Objetivo: Determinar la prevalencia de errores
asociados a la prescripción y/o administración de medicamentos en pacientes
admitidos en UCIP.
Determinar el tipo de error, el grupo de
fármacos que estuvo asociado y la severidad de daño.
Materiales y métodos: Estudio prospectivo observacional. Se
incluyeron todos los pacientes internados en UCIP entre junio de 2021 y junio
2022 en un hospital privado.
La recolección de los datos se realizó
mediante observación directa, monitoreo informatizado y reporte voluntario. Las
variables registradas fueron: edad, sexo, medicamento intervenido, tipo de
error, severidad de daño. Se consideraron errores de prescripción, validación,
preparación, dispensación y administración.
Resultados: Se admitieron a UCIP 921 pacientes. En un
total de 299 pacientes se detectaron 1148 errores, de los cuales 37,12% eran
lactantes y menores de 1 año; 34,78% niños de 1 a 11 años y 28,09% de 11 a 18
años. 55,66% eran de sexo masculino.
Los errores más frecuentes fueron: dosis o
frecuencia incorrecta (57,14%), indicación inapropiada de la dilución (11,50%),
indicación duplicada (5,05%), entre otros.
El 21,61% de errores alcanzó al paciente. Uno
solo produjo daño temporal y precisó tratamiento de intervención del equipo
médico.
Los daños evidenciados fueron: categoría B
con una frecuencia de 802 (69,86%), categoría C (21,52%), categoría D (0,52%) y
un único error de la categoría E (ketamina). No se registraron errores de
Categoría F, G, H o I.
Los fármacos que con mayor frecuencia fueron
Antiinfecciosos (16,46%), sedoanalgesia (8,32%), inmunosupresores y
quimioterápicos con 2,40%, entre otros.
Conclusiones: Los datos obtenidos dejan en evidencia que
los errores de medicación siguen siendo motivo de gran preocupación,
especialmente cuando se trata de la población pediátrica.
El proceso de validación farmacéutica
integrado a la prescripción electrónica resulta ser una herramienta eficaz para
evitar que el error alcance al paciente.


F Cometto, M
Jaime(1), HA Trillard(1), M Binci Vayer(2), S Dipente(2), E Guzman(1), S
Mattausch(1)
(1) Sanatorio Aconcagua. (2) Hospital Militar
Regional Córdoba.
El síndrome nefrótico en pacientes diabéticos
es debido en la mayor parte de los casos a la nefropatía diabética. Un subgrupo
de pacientes (15 a 50%) desarrolla insuficiencia renal progresiva, casi siempre
asociada con proteinurias masivas.
Paciente femenina de 62 años con antecedentes
de diabetes tipo II insulinorrequiriente, artrosis y reemplazo de cadera derecha ingresa
por insuficiencia respiratoria. Al examen disnea clase funcional IV, ortopnea,
edemas generalizados, hipertensión arterial (173/90) y desaturación (88%aa).
ECG: sinusal, ondas T negativas en V2 y V3. Laboratorio de ingreso (tabla 1).
Consultó previamente por síntomas similares, con hallazgo de proteinuria
aislada de 8049 mg/dl. Es valorada por nefrología, indicando bloqueo tubular, reposición
de albúmina, dosaje de marcadores inmunológicos y biopsia renal. Al 3° día
evoluciona con descenso de hemoglobina sin descompensación hemodinámica, se
transfunde 1 UGRS. Al 4° día, buena evolución clínica pasa a sala. Tras 72
horas reingresa por disnea secundaria a progresión de derrame pleural derecho, el cual
es drenado obteniéndose líquido claro tipo trasudado. Evoluciona febril,
hipertensa, se pancultiva e inicia tratamiento con piperacilina-tazobactam y
vancomicina.
El día 13° de internación se realiza punción
biopsia renal guiada por tomografía, ingresando a Terapia intensiva con
depresión del sensorio y mala mecánica ventilatoria, se intuba y conecta a ARM.
Evoluciona con oligoanuria, sin respuesta a diuréticos, se inicia terapia de
reemplazo renal. En los hemocultivos desarrolla cocos gram positivos, se
suspende piperacilina tazobactam. El día 20° de internación es extubada, y por
fallo de extubación, reintubada a las 24 horas. A los 15 días de ARM se realiza
traqueotomía quirúrgica sin complicaciones. El informe de anatomía patológica reveló
glomerulonefritis membranosa (GNM). A los 30 días de internación, evoluciona
con inestabilidad hemodinámica, mayor requerimiento de drogas vasoactivas y
paro cardiorrespiratorio, sin respuesta a maniobras de reanimación, obita.
La nefropatía diabética afecta la
microvasculatura renal causando hiperfiltración. Esto lleva a hipertrofia
glomerular, aumento de la superficie del capilar glomerular y alteraciones
hemodinámicas que contribuyen al desarrollo y/o progresión de esta enfermedad
El tratamiento incluye diuréticos, tromboprofilaxis, inhibidores del sistema
renina angiotensina aldosterona y terapia inmunomoduladora en casos más graves.


0125 SÍNDROME RIÑÓN-PULMÓN EN
PACIENTE CRÍTICO. REPORTE DE UN CASO CLÍNICO
F Cometto, M
Jaime(1), HA Trillard(1), M Binci Vayer(2), S Dipente(1), E Guzman(1), S
Mattausch(1)
(1) Sanatorio Aconcagua. (2) Hospital Militar
Regional Córdoba.
El síndrome riñón-pulmón (SRP) se define como
la combinación de hemorragia alveolar difusa (HAD) y glomerulonefritis, mediado
inmunológicamente, caracterizada por inflamación y necrosis vascular. La
mayoría de los pacientes ingresan a Terapia Intensiva por fallo respiratorio
agudo secundario a HAD y fallo renal.
Paciente femenina de 72 años, diabética insulinorrequiriente,
hipertensa, ingresa a sala con diagnóstico de neumopatía infecciosa de 1 semana
de evolución en tratamiento antibiótico con amoxicilina clavulánico. Refiere
fiebre y tos con expectoración hematopurulenta de 24 horas de evolución. Al
examen físico, rales crepitantes e hipoventilación en ambos campos pulmonares a
predominio izquierdo. Laboratorio de ingreso (tabla 1). La tomografía de tórax
reveló leve enfisema centrolobulillar bilateral a predominio de lóbulos
superiores, pequeños focos de consolidación alveolar confluentes, bilaterales a
predominio de lóbulos inferiores, micronódulos agrupados con patrón de árbol en
gemación y adenomegalias mediastinales pretraqueales e infracarinales de 10 y
14 mm respectivamente. Cumple tratamiento con piperacilina tazobactam y
vancomicina por 7 días. A los 10 días persiste febril y disneica, infectología
indica repetir hemocultivos y tomar muestras para BAAR, resultando ambos
negativos. Intercurre con síndrome anémico secundario a melena requiriendo
múltiples transfusiones de glóbulos rojos, y fallo renal agudo oligúrico,
valorada por nefrología, solicitando serología autoinmune (tabla 2). El día 19°
de internación ingresa a UTI por insuficiencia respiratoria, con signos de
sobrecarga hídrica por ecografía pulmonar bedside, se intuba y conecta a ARM.
Evoluciona oligúrica, sin respuesta a infusión de furosemida, requiriendo
hemodiálisis. Ante sospecha de SRP se inician pulsos de metilprednisolona por 5
días seguido de ciclofosfamida. Intercurre con fibrilación auricular sin
descompensación hemodinámica, responde a cardioversión farmacológica.
Evoluciona hemodinámicamente inestable, poca tolerancia a hemodiálisis y
aumento de drogas vasoactivas, el 7° de internación en UTI fallece.
La detección de anticuerpos anti-MBG, ANA y/o
ANCA es clave para el diagnóstico. La biopsia renal y pulmonar provee el
diagnóstico definitivo. El éxito del tratamiento depende de un rápido
reconocimiento, exclusión de infecciones y tratamiento específico que incluye
pulsos de metilprednisolona durante 3-5 días, seguido prednisona oral asociado
a ciclofosfamida. La edad y la creatinina sérica al ingreso son fuertes
predictores de supervivencia.


O Martinez(1), MC
Palacio(1), JC Medina(1), M Chamadoira(1), G Francini(1), N Aguilar(1), V
Murillo(1), J Camargo(1), F Avila(1), A Gutierrez(1), C Quintanilla(1), C
Reyes(1), T Canabal(1), M Beck(1)
(1) Sanatorio Anchorena Itoiz.
Introducción: La Endocarditis bacteriana derecha ubicada en
la Valvula de Eustaquio es una entidad rara. La valvula de Eustaquio es un
pliegue remanente embrionario situado entre la unión de la VCI y la auricula
derecha, nido para vegetaciones o trombos procedentes de extremidades, migran y
quedan atrapados en la Valvula ocasionando tromboembolismo pulmonar o embolia
paradójica.
Caso clínico: Paciente de sexo femenino de 83 años con
antecedentes de demencia y postrada e internación reciente en otra institución.
Acude a Guardia por fiebre, disnea e inestabilidad hemodinámica. Ingresa a
Cuidados Intensivos por shock séptico con requerimientos de reanimación de
fluidos, vasopresores y asistencia ventilatoria mecánica. Se realizan
pancultivos y se inicia esquema antibiótico de amplio espectro con Piperacilina
tazobactam y vancomicina. Se constata al examen físico flogosis en miembro
superior izquierdo, presentando trombosis superficial de MSI, múltiples
opacidades nodulares pulmonares bilaterales compatible con embolias sépticas.
Se realiza ecocardiograma transesofagico observando en aurícula derecha en la
desembocadura de la vena cava inferior, masa móvil heterogénea de 11 x 6 mm que
corresponde a Endocarditis de la Valvula de Eustaquio. Hemocultivos
Estafilococo meticilino resistente. Evoluciona con disfunción orgánica
múltiple, shock séptico refractario y fallece.
Discusión: La persistencia de la Valvula de Eustaquio
puede presentarse como una estructura móvil y elongada que se proyecta varios
cm en la aurícula derecha y puede ser confundida con un tumor, vegetación o
trombo. Puede predisponer a la persistencia de foramen oval permeable y actuar
como nido para vegetaciones endocardicas especialmente en pacientes adictos
endovenosos o portadores de dispositivos cardiacos. La Endocarditis bacteriana
derecha ubicada en la Valvula de Eustaquio es una entidad rara que presenta
embolias sépticas pulmonares como en el caso de nuestro paciente, por
tromboflebitis venosa en paciente añosa con comorbilidades, aunque el
diagnóstico fue precoz, la evolución fue desfavorable.
Conclusión: La Endocarditis bacteriana derecha de la
Valvula de Eustaquio es una entidad infrecuente por tal motivo existe poca
evidencia en la literatura.
0128 Rehabilitación Basada en
la Familia en pacientes Neuro-críticos. Impacto en la funcionalidad
R Gomez(1), E
Pereyra Zamora(1), V Monrroy(1), D Valdivia(1), L Castro(1), M Prodi(1)
(1) Enrique Vera Barros.
Los pacientes externados de UTI que padecen
secuelas neurológicas deben enfrentar situaciones complejas para acceder a
centros públicos especializados para continuar recuperando las funciones
perdidas. Es por ello que desde la unidad de cuidados críticos se implementó un
programa de RBF resaltando la importancia de la educación de la misma como
pilar de recuperación del paciente, realizando un plan terapéutico
personalizado implementado por un familiar entrenado durante la estadía en UTI
del paciente y así lograr disminuir las complicaciones que la falta de acceso a
la rehabilitación pudiesen ocasionarle; siendo el lugar de residencia y los
ingresos económicos determinantes para ello.
Se incluyeron 33 pacientes desde el 1 de
septiembre de 2021 al 30 de Abril 2022 cuyo motivo de ingreso en UTI fue la
injuria cerebral adquirida. A familiares de los mismos se los instó a
participar de la Rehabilitación y del manejo del paciente dentro de la unidad
planteando objetivos conjuntos del plan terapéutico, con el fin de personalizar
la asistencia. Un kinesiólogo asignado se encargaba de evaluar y educar a la
familia diariamente. Aquellas familias con mayor compromiso y con dificultad al
acceso a centros de rehabilitación públicos, ya sea por las distancias o por su
situación socioeconómica para acceder a los mismos fueron incluidos en el
programa RBF, quedando excluidos aquellos pacientes cuyas familias no mostraron
compromiso ni comprensión con la propuesta, pasando a ser el grupo control.
Se evaluó el grado de discapacidad al momento
del alta con la Glasgow Outcome scale (GOS) y con la Disability Rating Scale
(DRS) se realizó la evaluación de la funcionalidad siendo el punto de partida
para realizar el seguimiento a 30, 60 y 90 días.
El plan terapéutico incluía manejo de la vía
aérea artificial, movilizaciones activas, sedestación, bipedestación,
organización del ciclo sueño-vigilia, cuidados posturales, entre otros.
Destacamos que los 20 pacientes que
adhirieron al plan de RBF propuesta presentaron mejorías de la recuperación de
las funciones a los 30, 60, y 90 días comparados con el grupo control.


0129 MUCORMICOSIS RINORBITARIA:
REPORTE DE UN CASO CLÍNICO
F Cometto, L Luque
Aguada(1), N Leonardia(2), Facultad De Ciencias De La Salud, Universidad
Católica De Córdoba, M Garcia Keim(5), S Dipente(5), C Salcedo(5), G Squaglia
Acosta(5), RL Aguilera(6)
(1) Clinica Universitaria Reina Fabiola. (2)
Escuela De Odontología. (3) Facultad De
Ciencias De La Salud. (4) Universidad
Católica De Córdoba. (5) Hospital Militar Regional Córdoba. (6) Hsspital
Militar Regional Córdoba.
La mucormicosis es una infección oportunista
grave con elevada morbimortalidad que afecta frecuentemente a pacientes
inmunodeprimidos y diabéticos descompensados. Es producida por hongos
saprofitos aeróbicos de la familia de los Mucorales aislados de fuentes
ambientales. Penetran en el organismo por vía aérea, gastrointestinal o
cutánea. El diagnóstico se realiza mediante la demostración de hifas hialinas
gruesas no septadas, angioinvasion, y necrosis tisular.
Paciente femenina de 71 años con antecedentes
de diabetes tipo 2 insulinorrequiriente, hipertensión arterial, dislipemia,
obesidad y cardiopatía isquémica que ingresa a Terapia Intensiva por cetoacidosis
diabética, estupor y mala mecánica ventilatoria, requiere intubación y conexión
a ARM. Laboratorio de ingreso (tabla 1)
Evoluciona hemodinámicamente inestable,
requiriendo noradrenalina a dosis variables, anúrica sin respuesta a expansión
con cristaloides e infusión de diuréticos, al 3° día de internación se inicia
hemodiálisis.
El 6° día se objetiva lesión ulcerada en
región perianal. La ecografía mostró en tejido celular subcutáneo una imagen
hiperecogénica con sombra acústica posterior de 5 mm, probable calcificación,
sin evidencia de colecciones, responde a clindamicina. El 14° día se objetiva
lesión eritematosa, indurada en región malar izquierda, extendida al cuello. La
TAC de macizo facial y cuello reveló signos de pansinusitis, otomastoiditis y
tumefacción de partes blandas, se inicia tratamiento con cefazolina más
claritromicina. El 15° día evoluciona con destete fallido, siendo reintubada el
mismo día. La lesión en región malar izquierda, de aspecto necrótico y
extendida a paladar duro es biopsiada . Ante sospecha de mucormicosis se inicia
anfotericina B. El 20° día de internación presenta paro cardiorrespiratorio sin
respuesta a maniobras de reanimación.
La biopsia mostró hifas hialinas cenocíticas,
anchas, ramificadas con contornos irregulares y paredes gruesas (tabla 2). El
estudio de las características fenotípicas macroscópicas y microscópicas
identificó la cepa como Rhizopus sp, y por secuenciación parcial del ITS como
Rhizopus arrhizus.
La mucormicosis es una enfermedad grave con
pronóstico desfavorable y alta mortalidad cuya incidencia ha aumentado en los
últimos años. Debe evaluarse teniendo en cuenta la presentación clínica,
estudios de imágenes, exámenes directos positivos, desarrollo en cultivo puro y
anatomía patológica. Es fundamental la sospecha clínica precoz y el diagnóstico
temprano para instaurar un tratamiento oportuno y eficaz.


LJ Ojeda Flores(1),
K Velazquez(1), L Solis(1), M Gonzalez(1), LB Costa(1), C Pisarello(1), JE
Alfonso(1), J Bernachea(1), S Gamarra(1), V Gimenez(1), J Martinez(1), C
Mizdraji(1), L Huespe(1), S Lazzeri(1), H Alvarez(1)
(1) Hospital Escuela Gral. San Martin.
Introducción: En los últimos años se ha extendido
ampliamente ultrasonografía cerebral para detectar la presencia de aumento de
la presión intracraneal, para orientar el diagnóstico y el tratamiento.
Presentación de caso: Femenina de 58 años,
hipertensa, Diabética tipo II. El 23/07/2022 evoluciona con cefalea consultando
en su localidad, quedando internada. TC de cerebro que evidencia hematoma
parenquimatoso temporal derecho. Se decide su derivación. Ingresa al servicio
de emergencias ingresando vigil, con GSC 15/15. El 27/07/2022 evoluciona con
deterioro neurologico (GSC 9/15). TC de cerebro que evidencia edema cerebral
sin cambios en el volumen del hematoma. Score ICH 2 puntos. Se decide
evacuación de hematoma intracerebral, sin monitoreo invasivo de PIC. El
28/07/2022, se realiza medición de ONSD que evidencia 5.4 mm en ojo derecho y
6.2 mm en ojo izquierdo. Doppler transcraneal que informa hipoflujo a nivel de
ACM-L e IP 2.9. TC de cerebro que evidencia sangrado en sitio quirúrgico con
efecto de masa. Se decide evacuación de hematoma + craniectomia descompresiva,
con colocación de cateter de PIC subdural (umbral PIC de 15 -18 mmHg). Se
realiza traqueostomía percutánea. El 04/08/2022 se cierra sedación presentando
GSC 10/10. El 08/08/2020, se decide derivación a centro de menor complejidad
para neurorehabilitación.
Discusión: La importancia de la ecografía cerebral para
la evaluación, progresión y manejo de la hipertensión intracraneal en las UCI
ha sido ampliamente demostrada.
Conclusión: Nuestro caso permite destacar la importancia
en la medición de ONSD en conjunto con el doppler transcraneal para el
monitoreo no invasivo de la PIC.


0131 Monitoreo del Agua
Extravascular Pulmonar en COVID-19
D Duarte(1), G
Benavent(1), A Monson(1), Y Escobar(1), D Espinel(1), E Sanchez(1), J
Roldan(1), R Sanabria(1)
(1) Cemep.
Objetivo: Determinar el agua extravascular pulmonar
(AEVP) y el índice de permeabilidad (IP) en los pacientes con síndromes de
distres respiratorios del adulto (SDRA) secundario a infección por COVID 19
para predecir mortalidad.
Metodos: Estudio retrospectivo observacional,
descriptivo y analítico. Fueron incluidos todos los pacientes admitidos al
Servicio de Terapia Intensiva (STI) polivalente de adultos con diagnóstico de
insuficiencia respiratoria aguda (IRA) secundario a infección por Covid 19
desde el periodo comprendido entre julio de 2020 y julio 2021. Se dividido en 3
grupos de acuerdo a la severidad del SDRA: Grupo 1: SDRA Grave ( PAFI <100
), Grupo 2: SDRA Moderado ( PAFI 100-200), Grupo 3: SDRA Leve ( PAFI
200-300).Se registraron las siguientes variables: Sexo, edad, APACHE II, SOFA
al ingreso en el STI, presion arterial media (PAM),Frecuencia cardiaca (FC),
PAFI ingreso, dosis de noradrenalina (NADR), dobutamina (DB), Volumen Tidal
(VT),Frecuencia respiratoria (FR), Presión Plateau (PP) , Delta Presión (DP),
Fracción inspirada de oxígeno (FiO2), Balance de líquidos (BL), AEVP, IP,
estadía en el STI y mortalidad.
Resultados: Se evaluaron 192 pacientes (ptes), la edad
promedio 56+/- 16 años, la media de SAPS II 63 Los dias de ventilacion mecanica
fueron 19 dias (9-32), la media de estancia en el STI fue de 17 (12-43),
requirieron 19 % de reemplazo renal, la mortalidad global fue del 15.6 %(30
ptes). En el analisis bivariado no se encontraron diferencias estadisticamente
significativa entre sobrevivientes(S) y no sobrevivientes (NS) en las variables
edad, genero, SAPS II, IS,PAM, FC, BL,NADR y DBT. La diferencia
estadisticamente significativa se observó entre el grupo S y NS en las
variables. AEVP > 20 (70%)21 ptes versus AEVP < 20: 9 ptes (30%)p=0.005;
IP < 4 22 ptes (73.3%)versus IP>4 :8 ptes( 26.6%) p=0.003
Conclusion: Los pacientes con SDRA secundario a COVID 19
que presentaron AEVP >20 y IP < 4 tenian mayor mortalidad a 30 dias.
0132 FISTULA CAROTIDA-YUGULAR
TRAUMÁTICA TARDIA Reporte de caso
A Gutierrez(1), MC
Palacio(1), JC Medina(1), M Chamadoira(1), G Francini(1), N Aguilar(1), V
Murillo(1), O Martinez(1), J Camargo(1), F Avila(1), C Reyes(1), C
Quintanilla(1), T Canabal(1), M Pataro(1)
(1) Sanatorio Anchorena Itoiz.
Introducción: Las injurias carotídeas ocurren en el 22% de
las lesiones del cuello. En el 4 a 10% pueden producirse fístulas entre la
arteria carótida y vena yugular interna. El flujo venoso se incrementado,
pudiendo aparecer edema y/o isquemia cerebral. Las opciones terapéuticas
incluyen reparación quirúrgica, ligadura de la arteria carótida interna,
tratamiento endovascular con balón de oclusión, embolizacion con coils o stent
recubiertos.
Caso clínico: Paciente masculino de 42 años de edad con
antecedente de herida por arma de fuego a los 17 años de edad con proyectil
alojado en región cervical lateral izquierda zona II. Comienza hace 1 año y 5
meses con alteración de la memoria y atención, irritabilidad e hipersomnia.
Consulta a la guardia por deterioro cognitivo, desorientación temporoespacial,
lenguaje inapropiado y alteración en la marcha. Ingresa a Cuidados críticos
constatando al examen físico paciente desorientado con déficit cognitivo, abulia,
sin déficit motor. Se palpa en región cervical lateral izquierda masa pulsátil
y no dolorosa.
Se realiza tomografía de cerebro: Imagen
hipodensa en brazo posterior de cápsula interna izquierda de aspecto isquémico.
Angiotomografía de vasos del cuello y cerebro: Esquirla metálica en región
lateral izquierda del axis. Dilatación marcada de vena yugular izquierda y
arteria carótida común con dilatación varicosa de estructuras venosas
alcanzando los senos venosos, se observa fistula carótida-yugular izquierda. Se
realiza angiografía que reporta: arteria carótida interna izquierda
extracraneana a 2 cm de su origen, fístula arteriovenosa a vena yugular interna
izquierda. Evaluado por cirugía vascular, se realiza embolización de carótida
externa con amplatzer, y se colocan dos stents en carótida interna izquierda
distal. Evoluciona favorable.
Discusión: En nuestro caso el paciente presentaba una
fístula carótida-yugular de larga data (25 años) con hipoflujo arterial del
hemisferio cerebral izquierdo, compensado con circulación colateral y se
observó hipertensión venosa cerebral con dilatación de los senos venosos
cerebrales de larga data hasta la claudicación de los mecanismos de
compensación.
Conclusión: Es una patología de escasa frecuencia, más
aún fistula carótida-yugular de tardía ya que en la bibliografía se describen
casos agudos con tratamientos precoces y alta morbimortalidad. En nuestro caso
la entidad era de larga data y el tratamiento fue individualizado y
consensuado.
NE Sanchez(1), MA
Quijano(1)
(1) Dr. Arturo Oñativia.
Introducción: El noroeste argentino no escapo a los efectos
devastadores de la pandemia de COVID-19. Tampoco avanzo en sincronía a las
grandes ciudades del País. El Hospital Dr Arturo Oñativia recibió el primer
caso a fines de Julio de 2020. En la Provincia de Salta, los hospitales
públicos sesgaron su abordaje de acuerdo a la población objetivo. Nuestra institución
apunta al perfil de enfermedades endocrinometabólicas, siendo el principal
responsable de la atención a pacientes obesos.
Objetivo: Examinar las características y los resultados
de la ventilación mecánica invasiva (VMI) en pacientes con COVID-19 durante el
año 2021 en Unidad de Terapia Intensiva (UTI).
Método: Se describe la población y los resultados de
la experiencia de VMI de 1 año.
Resultados: 77 pacientes COVID-19 requirieron
internación en UTI. 49 (63%) emplearon VMI. La edad promedio fue de 50. El sexo
masculino constituyo el 68, 83% de la población. Los pacientes obesos
representaron el 76,34%, con Indice de Masa Corporal (IMC) promedio de 42,53.
La media de días de VMI fue 23 (min 5 max 109), el porcentaje de liberación de
VM 63,26%, la mortalidad en VMI 36,73%, mientras que la mortalidad general fue
de 23,37%.

Conclusiones: En comparación al estudio SATICOVID Argentina
nuestra población es en edad menor, la prevalencia por sexo presenta
similitudes. Se registró mayor porcentaje de obesidad. Los días de VMI fueron
mayores a los consignados, no obstante supone mayor porcentaje de liberación y
menor mortalidad a la reportada.
0134 TUBERCULOSIS NEONATAL
CONGÉNITA DISEMINADA. A PROPÓSITO DE UN CASO
J Jonas(1), MM
Reinares(1), J Manniello(1), MA Forchino(1), A Romagnoli(1), M Castilla(1), M
Allassia(1)
(1) Hospital De Niños Orlando Alassia.
Introducción: La tuberculosis neonatal es infrecuente, se
asocia a alta mortalidad y requiere de alto grado de sospecha para su diagnóstico.
Se diferencia en: forma congénita o adquirida postnatal.
La TBC congénita se presenta en RN hijos de
madres con enfermedad activa durante el embarazo o que presentan TBC genital.
Las madres con TBC diseminada o sin tratamiento, tienen mayor riesgo de
transmisión de la enfermedad.
La tasa de transmisión oscila entre 0-16%. En
2019 se notificaron al Sistema Nacional de Vigilancia de Salud 12.499 casos, y
los menores de 20 años representaron el 16,6%.
Presentación del caso: Paciente de 4 meses,
con antecedente de madre con tuberculosis pulmonar con baciloscopías positivas
sin tratamiento, sintomática en el tercer trimestre del embarazo, que presenta
detención pondoestatural al segundo mes de vida. Se realiza al neonato PPD
negativa y Rx tórax patológica, por lo que inicia tratamiento con
antituberculostáticos de primera línea. Por dificultades en la toma de
medicación, CVAS y desnutrición se decide su internación. Se realiza PCR en
materia fecal positiva a Mycobacterium Tuberculosis. Evolución desfavorable,
presenta hepatitis medicamentosa y fallo respiratorio por lo que ingresa a UCIP
de nuestro hospital.
Presenta imágenes compatibles con lesiones
por TBC en bazo e hígado, con diagnóstico evolutivo de TBC miliar. Ventilada
desde su ingreso. Por SDRA con hipoxemia refractaria se realizan medidas
adyuvantes como titulación de PEEP, decúbito prono y VAFO. Actualmente en ARM
con estabilidad clínica y gasométrica, realizando tratamiento
antituberculostático de 3era línea con mejoría de función hepática.
Conclusión: La tuberculosis continúa ocasionando
enfermedad y muerte en la población pediátrica. En la infancia hay mayor
probabilidad de progresión de la infección y mayor diseminación de esta que,
junto a la inespecificidad de la clínica, la menor capacidad de diagnóstico por
pruebas microbiológicas y las barreras terapéuticas, complican el manejo
óptimo. Cuanto menor es el niño, mayor riesgo de formas diseminadas y, si no se
tratan, mayor riesgo de complicaciones.


0135 PRESENTACION ATIPICA DE HIPERTIROIDISMO
EN PACIENTE CRITICO: PRESENTACION DE UN CASO
L Doldan(1), M
Galindo(1), C Vargas(1), C Dominguez(1), R Gregori(1), Y Lamberto(1), P
Saul(1), N Chacon(1), V Chediack(1), E Cunto(1)
(1) Muñiz.
Introducción: El diagnóstico de hipertiroidismo suele ser
evidente en pacientes con manifestaciones clínicas típicas. Sin embargo, se
plantea un desafío en pacientes críticos cuando no presentan clínica clásica
asociados a parámetros de laboratorio poco concluyentes.
Presentación del caso: Paciente femenina, 43 años. Antecedente de
convivencia con hermana con tuberculosis. Consultó por disnea progresiva de 48
horas de inicio, tos y expectoración hemoptoica.
Examen: taquicardia sinusal, hipertensión,
bradipsiquia, ictericia, piel seca, cabello ralo, edemas duros en miembros
inferiores con mixedema pretibial. Radiografía de tórax: infiltrados
bilaterales. Evolucionó con insuficiencia respiratoria, requerimiento de
asistencia ventiladora mecánica.
Laboratorio: anemia, plaquetopenia,
leucocitosis e hiperbilirrubinemia. Primer perfil tiroideo: Tirotrofina
indetectable, tiroxina normal.
Posteriormente, la paciente presentó
episodios de taquiarritmia supraventricular, que revirtieron con amiodarona.
Registros febriles, sin rescates microbiológicos en estudios reiterados.
Ecografía tiroidea: aumento de tamaño difuso
e hipervascularizacion. Segundo dosaje de Tirotrofina indetectable, tiroxina
elevada y anticuerpos anti receptor de tirotrofina positivos.
Se interpretó como crisis hipertiroidea.
Se inició tratamiento con betabloqueantes,
hidrocortisona y metimazol. Se derivò a otro centro para seguimiento por
Endocrinologìa.
Discusión: Los trastornos tiroideos pueden ser de
difícil diagnóstico en pacientes críticos, más aun con presentación clínica
atípica. La tirotrofina sérica es la mejor prueba inicial a solicitar. Sin
embargo, no se descarta con tirotrofina suprimida y tiroxina normal.
La tormenta tiroidea es una complicación que
se presenta solo en el 1% de los pacientes hipertiroideos; siendo la taquicardia,
fiebre y diarrea las manifestaciones cardinales. Con menor frecuencia, pueden
presentar signos de falla cardiaca y alteraciones hematológicas como
plaquetopenia mediada por anticuerpos.
Conclusión: En primer término, se interpretó el caso como
tuberculosis pulmonar dados los antecedentes de la paciente y las
manifestaciones clínicas. Sin rescate microbiológico en estudios repetidos
sumado a la persistencia de taquicardia y registros febriles con aumento del
metabolismo basal, llevaron a sospechar disfunción tiroidea. Si bien en este
caso la clínica era más compatible con hipotiroidismo, al realizar los dosajes
hormonales, se obtuvo el diagnostico de hiperfunción con criterios de tormenta
tiroidea presentando signos y síntomas de muy baja frecuencia.
E Walter(1), PI
Rossi(1)
(1) Hospital Provincial Neuquen.
Introducción: La rabdomiólisis es una enfermedad poco
frecuente en pediatría. El objetivo es presentar un paciente en el que se
desarrolló en contexto de shock séptico por COVID asociado a status convulsivo
febril e hipernatremia severa con acidosis metabólica.
Caso clínico: Niña de 2 años y 10 meses de edad con
antecedente de displasia septo-óptica, epilepsia e insuficiencia
corticosuprarrenal, que ingresa a la UTIP por status convulsivo refractario a
fármacos con requerimiento de ARM, en contexto de infección por COVID-19.
Ingresa con acidosis metabólica grave, hipernatremia e insuficiencia renal.
Al tercer día se constata elevación de
creatín fosfokinasa con un valor máximo de 59739 UI/l, es interpretado como
rabdomiólisis de origen multicausal. Se inició hiperhidratación y se fuerza
diuresis con furosemida. Presenta buena respuesta al tratamiento con descenso
de los parámetros de laboratorio. La niña obita por hipoxia refractaria al
tratamiento con SDRA secundario a COVID 19
Discusión: La rabdomiolisis es un síndrome que se
produce de forma secundaria al daño y la degradación muscular, poco frecuente
en pediatría y las principales causas se encuentran en las infecciones. La
injuria renal aguda por rabdomiolisis está presente en 7-10% de los casos y se
ha relacionado con tasas más altas de morbimortalidad. Por su infrecuencia en
la población infantil, por no tener una clínica clara y en situaciones donde el
estado de conciencia no puede valorarse adecuadamente es necesario tenerla en
cuenta y realizar un monitoreo de la misma de forma rutinaria.
Conclusión: El status convulsivo, y la hipernatremia
grave estan descritos como causa rara de rabdomiólisis e insuficiencia renal.
Actualmente también se puede describir la infección por COVID-19. En pacientes
críticos es importante un alto índice de sospecha de rabdomiólisis y
determinación seriada de la creatín fosfokinasa para su detección y tratamiento
precoz.

0138 REPORTE DE UN CASO DE UN PACIENTE PEDIÁTRICO CON DISECCIÓN DE AORTA
SEVERA POR HTA SECUNDARIA PSEUDOHIPOALDOSTERONISMO
AUTOSÓMICO RECESIVO
E Walter(1), PI
Rossi(1)
(1) Hospital Provincial Neuquen.
Introducción: El déficit de
11-beta-hidroxiesteroide-deshidrogenasa genera una HTA dependiente de
mineralocorticoides. A nivel renal, la aldosterona reabsorbe sodio y agua
aumentando el volumen intravascular y la presión arterial, sin diagnóstico ni
tratamiento puede llevar a complicaciones graves.
Caso clínico: Paciente de 12 años con antecedente ACV
hemorrágico (hematoma intraparenquimatoso a nivel cápsulo putaminal izquierdo)
con HTA de muy difícil manejo, no estudiada durante la infancia, con
nefrocalcinosis, hipernatremia e hipokalemia. TAC de vasos renales: doble
arteria renal derecha. Ecocardiograma con engrosamiento de pared libre de VI.
Regular seguimiento al alta.
Ingresa por 1 semana de evolución de disnea
funcional grado 2, y agrega dolor precordial agudo en reposo, no irradiado,
intensidad 10/10, crisis hipertensiva (208/150) hipernatremia e hipokalemia.
Enzimas cardiacas aumentadas. Soplo diastólico rudo.
Se realiza angioTAC: Aneurisma de aorta
disecante de inicio en coronaria izquierda hasta femoral derecha.
Se realiza cirugía de Benthal-Bono.
Postoperatorio: bloqueo AV completo, Bajo
gasto cardiaco severo e Hipertensión arterial de difícil manejo.
Anticoagulación profiláctica por válvula protésica.
A los 8 días presenta taponamiento cardíaco,
y Obito.
Diagnóstico postmortem: Deficiencia de
11-beta-hidroxiesteroide-deshidrogenasa.
Discusión: La disección aórtica presenta muy baja
incidencia en pediatría, debe sospecharse en presencia de dolor intenso,
torácico-abdominal, hipertensión y patología predisponente. Los métodos por
imágenes permiten el diagnóstico definitivo.
Conclusión: En las evaluaciones periódicas de los niños
es necesario el registro de la tensión arterial y el estudio de la hipertensión
de ser necesario. Hay múltiples causas y aun siendo infrecuentes las
alteraciones genéticas deben sospecharse para un diagnóstico y abordaje precoz
para evitar complicaciones potencialmente mortales.


G Genovese(1), MS
Tomez(1), M Deguardia(1), RG Ochoa(1), VN Terrazas Cruz(1), AK Marquez(1), IF
González Marquez(1), H Mamani Sánchez(1), MDLM Picos(1), A Antik(1), R
Rodrigues La Moglie(1), B Spath(1), FM Dana(1), M Izus(1)
(1) Durand.
Introducción: La OMS en febrero de 2020 designó la
enfermedad por SARS-CoV-2 como COVID-19. El espectro de la enfermedad puede
variar desde formas asintomáticas hasta neumonía grave y muerte. En Argentina
la mortalidad en UTI fue 57%. La edad, necesidad de ARM, PAFI, shock, dímero D
y falla renal son factores asociados a mal pronóstico.
Objetivo: Determinar los factores predictores de
mortalidad en pacientes con COVID-19 grave en ARM invasiva.
Material y métodos: Estudio observacional, analítico,
retrospectivo. Se incluyeron pacientes con resultado positivo confirmado para
COVID-19 con neumonía en ARM invasiva. Periodo: 31/3/20- 31/12/2021. UTI 2 -
Hospital C. G. Durand -CABA. Variable de resultado: mortalidad hospitalaria.
Como predictores se incluyeron: edad, sexo, PAFI ingreso, APACHE II, SOFA, DBT,
HTA, IRC, EPOC, oncológico, dimero D, ferritina, PCR, pronación, neumonía ARM,
neumotórax, diálisis, traqueostomía. Como medida de resumen se utilizó para
variables cuantitativas mediana e intervalo interquartilar, para variables
cualitativas frecuencia y porcentaje. Para evaluar la mortalidad y sus factores
pronósticos se realizó un análisis univariado y multivariado mediante regresión
logística modelando la mortalidad mediante odd ratio e IC 95%. Se consideró
significativa p < 0.05.
Resultados: de 404 pacientes ingresados a la unidad se
excluyeron: 121 pacientes que no requirieron ARM y 71 por datos incompletos. Se
analizaron 212 pacientes. La mediana de edad fue 62 (51-71), varones 71%, PAFI
ingreso 132 (96-170). Resto de las características basales ver tabla 1.
El análisis univariado identificó como
variables asociadas a mortalidad: edad (OR 1.06 IC95 1.03-1.084 p<0.001),
DBT (OR 2.89 IC95 1.27-6.57 p 0.011), HTA (OR 3.56 IC95 1.66-7.57 p 0.001),
EPOC (OR 5.64 IC95 1.02-9.97 p 0.020), APACHE II (OR 1.057 IC95 0.01-1.1 p
0.010), SOFA (OR 1.17 IC95 1.05-1.32 p 0.04), traqueostomía (OR 0.32 IC95
0.16-0.67 p 0.002).
En el análisis multivariado se observó que se
relacionaban con mortalidad: edad (OR 1.04 IC95 1.01-1.07 p 0.008), SOFA (OR
1.23 IC95 1.01-1.49 p 0.04), traqueostomía (OR 0.41 IC950.018-0.94 p 0.04).
Tabla 2.
Conclusiones: En nuestro grupo de pacientes los factores
predictores de mortalidad identificados fueron parámetros clínicos como edad,
SOFA y traqueostomía. Las variables de laboratorio no mostraron asociación.


AB Rojas(1), S
Chaile(1), M Dextre Primo(1), F Castro(1), D Reynoso(1), M Andreotti(1), JC
Vergottini(1)
(1) Hospital Nacional De Clinicas.
Introducción: La sepsis y shock séptico (SS) son verdaderas
emergencias médicas con necesidad de diagnóstico y tratamiento oportunos. El
lactato es un biomarcador de disfunción orgánica inducida por sepsis. En la
sepsis, el aumento del consumo de oxígeno promuevera el metabolismo anaerobio
generando hiperlactacidemia. El aclaramiento del ácido láctico se define como
la diferencia de sus niveles luego de las 6 horas. La falta de este
aclaramiento aumentara la mortalidad hospitalaria.
Objetivo: Determinar el valor del clearance del ácido
láctico en el pronóstico de los pacientes con sepsis y shock séptico en la
Unidad de Terapia Intensiva del Hospital Nacional de Clínicas.
Materiales y métodos: Estudio observacional, descriptivo y de corte
longitudinal que incluyó a 40 pacientes con diagnóstico de Sepsis y Shock
Séptico, a los cuales se les realizó mediciones seriadas de: Ácido láctico, al
momento del ingreso a UTI, a las 6, 12, 18 y 24 hs. Dichos pacientes fueron
clasificados en fallecidos y no fallecidos a los 30 días del ingreso.
Resultados: Se incluyeron 40 pacientes, con un promedio
de edad de 68 ± 10 años y de los cuales el 53% (n=21) fueron de sexo femenino.
Al ingreso a UTI, los pacientes fallecidos presentaron valores de ácido láctico
promedios de 4,5 mmol/L, sin embargo, en los sobrevivientes, dichos valores descendieron
desde los 3,80 ± 2,24 mmol/L iniciales, hasta 2,34 ± 1,74 mmol/L a las 24 hs.
Estas diferencias fueron estadísticamente significativas (p-valor <0,0001).
Al analizar los valores de aclaramiento de ácido láctico en el grupo de
fallecidos y sobrevivientes, se observó que en los primeros los valores de
aclaramiento fueron menores que los segundos (12,5 ± 10 mmol/L vs 34 ±25
mmol/L). Las diferencias fueron estadísticamente significativas (p-valor:
0,0141).
Conclusión: En los pacientes con sepsis y shock séptico
el descenso del ácido láctico, así como su aclaramiento se asociaron a una
mayor supervivencia y mejor pronóstico a los 30 días.


0141 Osificación Heterotópica
en COVID-19, ¿La asociación aún no documentada? Reporte de dos casos
L Aren(1), GF
Mayer(1), J Hernandez(1)
(1) Madre Catalina Rodriguez.
Se define como osificación heterotópica (OH)
a la formación de tejido óseo en zonas de tejido blando en donde habitualmente
no hay hueso. Se trata de una patología rara/subdiagnosticada habitualmente
relacionada con parálisis e inmovilización durante el curso crítico de
traumatismos, lesiones neurológicas, síndrome de dificultad respiratoria aguda
(SDRA), cirugías o grandes quemados. En el transcurso de la pandemia por
SARS-CoV2 se reportaron casos de pacientes críticos con OH interpretándose que
la magnitud de la reacción inflamatoria, posible efecto propio del virus, y
largos periodos de inmovilización mientras transcurría la etapa crítica podrían
ser los determinantes de esta entidad clínica.
Durante el período de internación de los
casos que describiremos a continuación, el porcentaje ocupacional fue de 166 %
y 200 % y la carga laboral del personal de enfermería, medida por TISS-28, fue
de 72 puntos, excediéndose casi al doble de las posibilidades laborales. Al
mismo tiempo la rehabilitación motora, por parte del equipo de kinesiología, se
vio postergada ante la necesidad de atender circunstancias urgentes como la
optimización del soporte ventilatorio y la participación en maniobras de cambios
de decúbito. De este modo interpretamos que la gran sobrecarga laboral
acontecida durante la pandemia condicionó una inadecuada provisión de
movilización temprana dando como resultado una mayor prevalencia de OH en
pacientes post COVID grave cuando se la compara con SDRA por otras causas.
Presentamos dos casos de OH en pacientes que
cursaron SDRA por SARS-CoV2 en momentos de alta carga laboral.


0144 Intoxicación con Ácido
Valproico: reporte de casos
L Morales(1), P
Pahnke(1), A Vilkelis(1)
(1) Hospital Municipal De Urgencias.
Introducción: El Ácido Valproico, usado para epilepsia,
patologías psiquiátricas, dolor neuropático y migrañas, puede provocar
intoxicaciones en altas dosis, aunque también en rango terapéutico, consecuencia
de sus metabolitos activos. Principalmente son alteraciones neurológicas,
cardiovasculares y digestivas; especialmente coma e inestabilidad hemodinámica.
El tratamiento se basa en medidas de soporte; aumentar el metabolismo, usando
L-carnitina para mejorar la disfunción mitocondrial; o la eliminación
extracorpórea por su bajo peso molecular y unión a proteínas saturable.
Presentación de casos: Caso 1: Femenina, 17 años, traída por
servicio prehospitalario con depresión del sensorio al ingerir Divalproato de
Sodio 25000 mg, Sertralina 100 mg y Clotiapina 80 mg, en intento autolítico.
Ingresa hipotensa, taquicárdica, GCS 9/15. Requiere intubación orotraqueal y
vasopresores. Evoluciona con coagulopatía, hipoglucemia, injuria renal aguda,
hipernatremia, acidosis metabólica, extrasístoles ventriculares y
trombocitopenia. Se realiza medidas de desintoxicación, L-carnitina y diálisis
precoz. Complica con rabdomiólisis y neumonía intrahospitalaria. Se otorga alta
al 11º día.
Caso 2: Masculino, 22 años, que consume
Divalproato de Sodio, Olanzapina y Clonazepam en dosis desconocidas, en intento
autolítico. Somnoliento, GCS 10/15, que evoluciona con requerimiento de
intubación orotraqueal. Dosajes séricos de Ácido Valproico dentro del rango
terapéutico pero con amonio sérico elevado. Se otorga alta al día 13.
Caso 3, 4 y 5: Pacientes que en intento
autolítico consumen medicación psiquiátrica, con dosis de Ácido Valproico 1750
mg, 250 mg y 14500 mg. Ingresan asintomáticos o con síntomas leves, por lo que
se realizan medidas de desintoxicación generales.
Discusión: Se describen numerosas manifestaciones
clínicas por intoxicación con Ácido Valproico, que se vieron reflejadas en su
mayoría en el caso 1. Estas manifestaciones pueden presentarse aún con dosajes
en rango terapéutico, tal como en el caso 2, debido a los metabolitos. Sin
embargo, al igual que lo establece la literatura, son más frecuentes las
intoxicaciones leves, que solo requieren monitoreo, desintoxicación y medidas
de sostén.
Conclusión: Es extenso el uso de Ácido Valproico para el
manejo de múltiples patologías y su intoxicación, potencialmente mortal, tiene
diversas manifestaciones clínicas, lo que hace difícil su diagnóstico si no
existe un alto índice de sospecha. Sin embargo, el óptimo tratamiento tiene
buenos resultados.
0145 ESTIMACIÓN DEL VOLUMEN
PLASMÁTICO Y MORTALIDAD POR SEPSIS EN UNIDAD DE CUIDADOS CRÍTICOS
MC Pohlemann
Tarnovski, S Ribak(1), E Carrera(1), A Villalba(1), C Farquharson(1), N
Barreto(1), A Matías(1), R Villalba(1), M Kaechele(1), A Alarcón(1), D
Acosta(1), C Correia(1)
(1) Hospital Escuela De Agudos Dr Ramón
Madariaga.
Introducción: La mortalidad por sepsis ronda el 22%, con un
pico de 40% en el shock séptico. Sólo una minoría de los pacientes tiene una
presentación clínica clara antes de su admisión en la Unidad de Cuidados
Críticos (UCI). El reconocimiento rápido del deterioro microvascular, que
podría conducir a una falla sistémica, es crucial para la terapia temprana y
para la supervivencia. La estimación de volumen Plasmático (ePVS) y su
elevación sería un marcador pronóstico útil en pacientes que aún no han tenido
repercusión macrohemodinámica. Nuestro objetivo es determinar la sensibilidad
del ePVS en pacientes con sepsis y shock séptico para predecir mortalidad
comparando con scores validados como el SOFA.
Métodos: Se incluyeron 96 pacientes internados en UCI
del Hospital de Agudos Dr Ramón Madariaga, Misiones, durante el período de
Enero a Diciembre 2021 que ingresaron por Sepsis o shock séptico. Se
registraron datos demográficos, calculando SOFA. El valor de la ePVS se obtuvo
con hematocrito y hemoglobina de ingreso a UCI, como punto de corte un valor
> 4,52 dl/g; empleando la fórmula: 100 – Hto (%) / Hb (g/dl).
Resultados: Fueron incluidos 96 pacientes (67% Masculinos
y 33% femeninas), edad media 63 ± 12 años, de los cuales el 79% presentaban
valores de ePVS mayor a 4,52dl/g al ingreso a UTI, de ellos un 70% presentó un
valor de SOFA mayor a 8. El 75% de pacientes con ePVS elevado fallecieron durante
la internación. De los pacientes que presentó SOFA > 8, el 93% falleció.
Conclusión: El valor de ePVS para predecir mortalidad en
pacientes con sepsis y shock séptico internados en UCI es una herramienta útil
comparando con otros scores como el SOFA, siendo el primero más rápido y
sencillo de calcular. Resta confirmar estos hallazgos en mayor número de
pacientes y con otros scores pronósticos de UTI como el APACHE II y el SAPS.


I Cruz Muñoz(1), AE
Carrera(2), SD Riback(2), R Ostrowski(2), C Correia Dasilva(2), N Barreto(2), M
Arguello(2), M Pohlemann(2), AJ Alarcón Marinoni(2), D Acosta(2), L Santana(2),
R Contreras(2), M Rodriguez(2), M Kaechele(2)
(1) Hospital Escuela Dr Ramón Madariaga. (2)
Hospital Madariaga.
Introducción: La incidencia de infección y/o colonización
fúngica en pacientes gravemente enfermos ha aumentado en las últimas décadas;
aproximadamente un tercio de ellas que se diagnostican en un hospital tienen
lugar en pacientes ingresados en las unidades de cuidados intensivos (UCI).
Nuestro objetivo es conocer las infecciones fúngicas en pacientes de UTI del
Hospital Escuela de Agudos Dr. Ramón Madariaga de Posadas Misiones.
Materiales y métodos: Estudio retrospectivo en el que se incluyó
pacientes internados en la UCI con sospecha o probabilidad de infección fúngica
utilizando el candida score; desde enero 2021 a enero 2022, para determinar la
presencia de hongos en alguna muestra biológica durante su estadía. La
obtención de los datos se realizó a través de la transcripción de los
resultados de cultivos y antifungigrama de las diferentes muestras procesadas
que incluyeron sangre, secreción traqueal, orina, punta de catéter central. Los
aislamientos fueron cultivados en agar y se incubaron por siete días a 28°C. Se
realizó revisión diaria de las placas por el servicio de bacteriología y
micología.
Resultados: Se analizaron 288 muestras biológicas que
correspondian a 72 pacientes internados en UCI, de estos en 31 (43.06%)
pacientes con total de 49 muestras biológicas se obtuvo aislamiento de hongos,
de los cuales el 40 % (20) fueron en hemocultivos, seguidos en frecuencia en secreción
traqueal con 30% (15), secreción abdominal con 14% (7), en catéter venoso
central 12%; y sólo 4% en orina. Los géneros más comunes causantes de
infecciones por hongos es la Cándida, siendo la más frecuente la C. albicans
que fue aislado en el 66.6 % de las muestras. (Tabla N° 1- Gráfico 2)
Conclusión: Demostramos que el 43.06 % de los pacientes
ingresados en la Unidad de Cuidados Intensivos del Hospital HEDADRM se aíslan
hongos con mayor porcentaje desarrollado en hemocultivos, y que existe una alta
incidencia de desarrollo de esta infección más que en otras series revisadas.
Candida albicans resultó la especie mayormente identificada en las muestras, lo
cual si es similar. Nos faltaría un análisis más exhaustivo para determinar
esta diferencia encontrada.

0149 Pancreatitis aguda severa
por hipertrigliceridemia: presentación de un caso y su tratamiento
M Agosta(1), DH
Gonzalez(1), M Curone(1), J Roque(1), J Etcheverria Trigo(1), F Pecoraro(1), L
De Bari(1), L Buira(1)
(1) Clinica Y Maternidad Suizo Argentina.
Introducción: La hipertrigliceridemia es la tercera causa
más frecuente de pancreatitis aguda, considerándose de alto riesgo para su
desarrollo los valores superiores a 1000mg/dL. Estos pacientes tienen peor
pronóstico que aquellos que cursan la enfermedad por cualquier otra etiología.
Presentación del caso: Paciente femenina de 39 años de edad con
antecedentes de obesidad, hipertrigliceridemia familiar, colecistectomizada y
pancreatitis a repetición desde los 17 años de edad. Medicada con fenofibratos.
Cursaba internación en sala general por pancreatitis secundaria a
hipertrigliceridemia con triglicéridos de 15000mg/dL y lipasa de 2694mg/dL.
Empeora con disnea, falla renal aguda e hipotensión arterial. Tomografía
computada contrastada que reportó pancreatitis aguda balthazar D con
trigliceridemia en aumento. Finalmente, admitida en Terapia Intensiva para
reanimación, monitoreo, medicion de presion intraabdominal e inicio de
plasmaféresis. Con dos sesiones de aféresis mejora el valor de triglicéridos a
2000mg/dL, con franca mejoría clínica y alta hospitalaria a la semana.
Discusión: Se recomienda medir los valores de
triglicéridos en los cuadros de pancreatitis aguda, dado que la hiperlipemia se
presenta como causa de esta enfermedad, pudiendo empeorar el manejo de la
patología de base.
Conclusión: La pancreatitis aguda es una complicación
temida en la hipertrigliceridemia. Debido a mayor riesgo de desarrollar forma
grave de la enfermedad, es de importancia un diagnóstico temprano para iniciar
un enfoque terapéutico.

JI Simonassi(1), MT
Canzobre(1), M Ricciardelli
(1) Garrahan.
Introducción: La falla respiratoria aguda (FRA) es la
principal causa de ingreso a unidad de cuidados intensivos pediátricos (UCIP)
en los pacientes menores de 1 año. En las últimas décadas la ventilación
mecánica no invasiva (VMNI) surge como una estrategia de sostén frente a la
FRA, pudiendo reducir la necesidad de intubación.
Objetivo: Identificar factores de riesgo de fracaso de
la VMNI en pacientes menores de 1 año con diagnóstico de FRA. Secundariamente
describir las características de esta población y comparar la evolución entre
quienes tuvieron éxito y aquellos que fracasaron.
Métodos: Se realizó un estudio de cohorte
observacional retrospectivo, durante enero de 2018 y diciembre de 2021, en una
UCIP polivalente. Se incluyeron todos los pacientes menores de 1 año con
diagnóstico de FRA que requirieron VMNI con el fin de evitar la intubación.
Resultados: Se analizaron 176 sujetos con una mediana de
edad de 4 (RIQ 2-7) meses y 6 (RIQ 5-7,7) kilos, de los cuales 77 (37%) tenían
una condición crónica compleja y 16 (9%) síndrome genético. Se diagnosticó
bronquiolitis a 163 (93%) y al resto neumonía. Murieron 4 niños (2%). Las
características generales de la población, su evolución y comparación se
desarrollan en la tabla 1. La VMNI se inició en la UCIP en 136 (77,3%) sujetos
y el resto en el departamento de emergencia, con una mediana de 2 (1-4) días,
evitando la intubación en 102 (58%). Más de la mitad de los fracasos se
produjeron dentro de las primeras 12 horas (59,5%), siendo la fatiga muscular
la causa más frecuente (76%). Hubo 6 (3,4%) complicaciones asociadas a la VMNI.
En la tabla 2 se desarrolla el análisis de regresión logística.
Conclusión: El inicio de síntomas mayor a 2 días al
momento de iniciar la VMNI, tener un score de Tal mayor a 10 e ingresar con un
PIM 3 igual o mayor a 0.6 mostraron ser factores de riesgo independientes de
fracaso de la VMNI. Los pacientes que respondieron exitosamente a la VMNI
tuvieron una estadía más corta tanto en UCIP como hospitalaria.
![]()

0152 PERICARDITIS CONSTRICTIVA: A PROPÓSITO DE UN
CASO
I Bollati(1), N
Buzzi(1), A Garcia(1), M Brizuela(1), E Asinari(1)
(1) Misericordia Nuevo Siglo.
Introducción: La pericarditis constrictiva, representa una
forma de falla cardiaca diastólica severa, secundaria a un pericardio no
complaciente. Se trata de una entidad nosológica de presentación poco frecuente
de incidencia no establecida en la literatura. Su etiología puede ser
postcardiocirugía, actínica, idiopática o tuberculosa entre otras. Las técnicas
de imágenes no invasivas al pie de cama aportan
información clínica que acelera el proceso
diagnóstico. Presentamos el siguiente caso clínico, de un paciente con
pericarditis constrictiva.
Caso clínico: Hombre de 67 años de edad, sin antecedentes
patológicos conocidos, que consulta por disnea de esfuerzo progresiva que llega
a clase funcional IV y se asocia a edema escrotal y en miembros inferiores. Al
examen presenta pulsos disminuidos, R1 y R2 hipofonéticos e irregulares, ingurgitación
yugular, anasarca, cianosis periférica, frialdad acral y oliguria.
Electrocardiograma con
fibrilación auricular de alta respuesta
ventricular. Inicia infusión de furosemida, anticoagulación, y oxigenoterapia
con buena respuesta clínica.
Evoluciona con hipotensión y anuria, inicia
infusión de dobutamina y noradrenalina con regular respuesta. Horas después
sufre deterioro hemodinámico y parada cardiaca reanimada con exito.
Al ecocardiograma se visualiza pericardio
hiperecogénico y engrosado, movimiento paradojal delseptum ventricular. En la
radiografía directa de tórax se visualiza silueta cardiaca con densidad
cálcica, con lo que se diagnostica pericarditis constrictiva por pericardio
calcificado.
El paciente es derivado a una institución de
mayor complejidad para tratamiento y fallece.
Discusión: La pericarditis constrictiva es una causa de
falla cardiaca diastólica infrecuente, curable, y de variadas etiologías, que
debido a sus implicancias pronósticas debe ser tenida en cuenta como
diagnóstico diferencial junto con valvulopatías y miocardiopatia restrictiva.
Sus características ecocardiográficas son
consecuencia de su patrón hemodinámico, con elevación de presiones de llenado
ventriculares, ecualización de presiones telediastólicas, disociación de
presiones cardiotorácicas y discordancia biventricular, generando el bamboleo
septal y el desplazamiento respirofásico del septum. La calcificación
pericárdica se da en el 25-30% de los casos.
Conclusión: La pericarditis constrictiva es una causa
poco frecuente e infradiagnosticada de insuficiencia cardiaca, que requiere una
alta sospecha clínica y manejo en centros especializados. La ecografía
al pie de cama representa una herramienta que
puede agilizar el diagnóstico de esta entidad.


0153 MIASTENIA GRAVIS DE NUEVA
APARICION POST VACUNACION CONTRAL EL SARS-COV-2. REPORTE DE CASO
M Martinez, LC
Avila(1), EC Rodriguez(1)
(1) Instituto Medico Rio Cuarto.
Introducción: La MG es una enfermedad de la unión neuromuscular
que afecta los músculos esqueléticos bulbares, respiratorios y de las
extremidades, presentando ACRA e impidiendo la transmisión de la cascada
excitatoria durante la contracción muscular.
La MG se controla con inhibidores de la aChR,
esteroides, inmunosupresores y/o timectomías. Las exacerbaciones pueden ser
inducidas por multiples causas. Reportamos un caso de una crisis de MG inducida
por la vacuna AstraZeneca.
Presentación del caso: Mujer de 61 años de edad, que presenta
disfonía y faringitis 11 días post 2° dosis de vacuna AstraZeneca.
Ingresa por parestesias y debilidad
generalizada. A las 24 hs evolución tórpida, ingresa a UTI, por incremento de
cuadriparesia, hiporeflexia, disfagia, disfonía, disartria, reflejo tusígeno
presente, pimax -15 pemax +10, ptosis palpebral bilateral, diplopía. Episodios
de disautonomia. IOT y ARM.
Laboratorio: serologías virales negativas,
LCR: sin particularidades, colagenograma ACRA + 13523.
Tratamiento con piridostigmina,
Inmunoglobulina humana y pulsos de Metil-Prednisolona.
Dia 3 se realiza traqueostomia precoz y
suspencion de sedación.
Dia 7 sin respuesta a estímulos y reflejos
bulbares abolidos, EEG: normal.
Dia 10-13 respuesta al dolor y movilización
parcial de extremidades. Nueva PL: aumento de proteínas.
Dia 15-20 movilización de tronco. Apertura
ocular y bucal.
Dia 40 PSV, moviliza hombros.
Dia 51 traqueo en T/PSV
Dia 70 moviliza cabeza y cuello.
Dia 77-98 weaning ARM, cánula fonatoria.
Dia 102 Deglución apropiada, pase a sala
general.
Dia 110 alta.
1mes al alta: score de rankin modificado: 0
Discusión: Se publicaron diversos trabajos de paciente
que padecían MG y sus complicaciones en la infección por SARS-COV-2, hasta el
momento en la literatura hay pocos casos de MG de nueva aparición post vacunación
contra SARS-CoV-2. La tormenta de citoquinas presentada en COVID-19 exacerba
los síntomas de MG.
Conclusión: Los trastornos inmunomediados de nueva
aparición después de la vacunación son infrecuentes. Esta serie de casos
destaca la importancia de reconocer los trastornos inmunomediados relacionados
con la vacunación contra el SARS-CoV-2. No está claro si la vacuna está
causalmente relacionada con el desarrollo de MG o si se trata de una ocurrencia
aleatoria y las evidencias que respaldan una relación causal son escasas.


E Gonzalez(1), A
Bianchi(1), N Göldy(1), N Ortiz(1), J Gironacci(1), A Borgherini(1), G Izaguirre(1),
L Talamonti(1), S Sanchez(1), G Elias(1)
(1) Hospital Provincial Rosario.
Introducción: La crisis miasténica se caracteriza por
debilidad severa de los músculos respiratorios y bulbares, puede requerir
soporte ventilatorio mecánico. Puede desencadenarse por factores ambientales,
infecciones, medicamentos, embarazo, etc.
El tratamiento consta de soporte
ventilatorio, inmunoterapia con plasmaféresis o inmunoglobulina y soporte vital
en cuidados críticos, pudiendo presentar complicaciones como infecciones
pulmonares, alteraciones hemodinámicas y dificultad para el destete.
Presentación del caso: Mujer de 19 años con diagnóstico previo de
miastenia gravis, timoma en plan quirúrgico, tabaquista y cursando su primer
embarazo, que ingresa a UTI por post operatorio de cesárea de urgencia por
crisis miasténica asociada a Sars Cov2 y preeclamsia severa tardia complicada
con PRES que requirió ARM y tratamiento con inmunoglobulina.
Discusión: El embarazo es uno de los factores que pueden
desencadenar una crisis miasténica por lo cual el tratamiento es la
finalización del mismo y tratamiento con piridostigmina. La complicación con
preeclamsia severa tardia es rara y en este contexto se torna dificultoso el
tratamiento ya que está contraindicado el sulfato de magnesio por la miastenia,
si bien el alumbramiento es el tratamiento de base.
La prevalencia de COVID 19 en miastenia
gravis no difiere con respecto a la población en general y no se correlaciona
con la gravedad.
La preeclampsia severa tardía se asocia a
PRES que resulta ser reversible con el control de la tensión arterial.
La administración de inmunoglobulina es
eficaz en las crisis que no revierten con anticolinesterásicos.
Se recomienda el uso de VNI así como la
intubación orotraqueal preventiva.
Conclusión: En nuestro caso se realizó cesárea,
tratamiento antihipertensivo, ARM e inmunoglobulina endovenosa con buena
evolución. Al presentar esta superposición de patologías que complican su
embarazo: crisis miasténica, preeclampsia tardía asociada a PRES más las
limitaciones del uso de fármacos que están contraindicados en las miastenia
gravis planteamos la presentación del caso por el desafío terapéutico que
implica.
0155 HEMATOMA INTRAMIOCARDIO
DISCECANTE POST INFARTO AGUDO MIOCARDIO
YS Talmas
Hurtado(1), N Tello(1), L Del Rio(1), G Izzo(1), E Velasquez(1), J Angulo(1), E
Rodriguez(1)
(1) Hzga Simplemente Evita.
Introducción: El hematoma disecante intramiocardio es una
complicación mecánica del infarto agudo de miocardio (IAM), una neocavitación
causada por la disección hemorrágica entre las fibras espirales miocárdicas. En
algunos casos se asocia a daño por reperfusión posterior a trombólisis o
revascularización percutánea. El 54% de los casos su diagnóstico es postmortem,
el 9% se evidencio ruptura del hematoma.
Varón de 54 años, antecedentes de tabaquismo,
hipertensión, diabetes, infarto de cara inferior (2016). Ingresa por SCACEST de
cara antero septal, en periodo de ventana, recibe terapia trombolítica con
estreptoquinasa, sin criterio de reperfusión, evolucionando a shock
cardiogénico, IOT/ARM, requerimiento de vasopresor/inotrópico, ecocardiograma:
FEVI 29% Simpson, VI: HVI a predominio septo basal dilatación leve con
hipocinesia global, AI: dilatación leve, FDVI patrón Bifásico restrictivo,
hallazgo en región lateral basal medial y apical, imagen compatible con
hematoma organizado, Doppler sin flujo (fig 1). Evoluciona con falla renal
aguda requiriendo diálisis. Shock refractario se plantea tratamiento
conservador, monitoreo ecocardiográfico con hematoma estable. 3ra semana
Cinecoronariografia: lesión severa de art. descendente anterior, angioplastia
con implante de un stent convencional, Art. Circunfleja ocluida. 4ta semana,
ecocardiograma con disminución de tamaño de hematoma.
Se trata de un hematoma disecante
intramiocardio (HDI) diagnosticado mediante ecocardiografía, manifestándose con
shock cardiogénico. Mayor frecuencia en SCACEST cara anteroposterior.
Relacionado principalmente con trombólisis y angioplastia coronaria transluminal
percutánea (ACTP) en tejido isquémico. En la mayoría de los casos su
diagnóstico es postmortem. Se debe sospechar ante la persistencia de elevación
ST más de 72 h. Diagnóstico diferencial trombos/aneurismas VI. Siendo el
ecocardiograma la herramienta más útil para su diagnóstico, monitoreo y
decisiones terapéuticas
Su tratamiento es controvertido, incluyen
manejo conservador esperando reabsorción del hematoma Vs evacuación quirúrgica
y reparación del VI. La decisión de tratamiento se puede tomar en función de la
estabilidad hemodinámica, extensión del hematoma y disfunción del VI.
En resumen, la HDI es una complicación
mecánica rara IAM con alta mortalidad. Dada la falta de protocolos de
tratamiento, el manejo debe ser individualizado.

0156 INCIDENCIA DE
COMPLICACIONES TARDÍAS EN TRAQUEOSTOMIAS PERCUTÁNEAS
VI Reichert(1), N
Carrizo(1), A Marozzi(1), M Filippi(1), L Morano(1), R Avila(1)
(1) Jose Maria Cullen.
Introducción: La traqueostomía percutánea, representa en la
actualidad, un procedimiento invasivo habitual para el manejo de pacientes con
asistencia respiratoria mecánica (ARM) prolongada. Las complicaciones
inmediatas al procedimiento han sido bien documentadas por numerosas series,
pero aquellas tardías, como estenosis, granulomas o fístulas, son difíciles de
registrar debido a la alta mortalidad de este grupo de pacientes, problemas
médicos persistentes, renuencia a los controles ambulatorios y ausencia de
síntomas.
Objetivo: Describir la incidencia de complicaciones
tardías, mediante controles ambulatorios con fibroscopio, de pacientes que
requirieron traqueostomía percutánea durante su estadía en terapia intensiva.
Método: Estudio descriptivo y retrospectivo
utilizando la base de datos de la Unidad de Terapia Intensiva y del Servicio de
Cirugía de Cabeza y Cuello del Hospital Provincial José M. Cullen.
Resultados: Desde octubre 2016 hasta agosto 2018 se
realizaron en nuestra terapia intensiva 227 traqueostomías percutáneas. La edad
promedio fue de 37 años y el score Apache de 18,6. Motivos de ingreso:
Politraumatismo 148 pacientes (65,19%), patologías médicas 69 (30,39%) y
quirúrgicas 10 (4,4%). Técnica de traqueostomía: Griggs 58% y Ciaglia 42%; 78
de los 227 procedimientos fueron guiados endoscópicamente. La mortalidad fue del
23,34% (53 pacientes); de los 174 sobrevivientes, solo 70 (40,2%) se
presentaron en forma ambulatoria para el control endoscópico. Se diagnosticaron
22 complicaciones (13 estenosis, 3 granulomas, 2 retrotraqueítis, 1 fístula
traqueoesofágica, 1 fístula traqueocutánea persitente, 1 parálisis de cuerda
vocal y 1 papiloma). De los 70 pacientes, el promedio de estadía en UTI fue de
27,47 días; el tiempo promedio desde inicio de ARM a traqueostomía fue de 12,11
días; los días totales en ARM de los pacientes sin complicaciones tardías fue
de 23,28 y en aquellos con complicaciones fue de 25,5 días.
Conclusión: A diferencia de otras publicaciones, en
nuestra serie, se presentaron a control de la vía aérea un 40% de los
sobrevivientes; se encontraron 22 lesiones laringotraqueales en 16 pacientes
(incidencia de 22,85%), las más frecuentes fueron estenosis (59%) y granulomas
(13.6%). De los 13 pacientes con estenosis traqueal, 10 fueron severas y
necesitaron tratamiento quirúrgico, dilatación o stent.


0157 SÍNDROME DE
VASOCONSTRICCIÓN CEREBRAL REVERSIBLE: SERIE DE CASOS
MV Gonzalez(1), CG
Videla(1), NM Ciarrocchi(1), E San Román(1), JF Sinner(1)
(1) Hospital Italiano De Buenos Aires.
Introducción: El síndrome de vasoconstricción cerebral reversible
(SVCR) es una entidad caracterizada por cefalea severa “en estallido” que puede
presentarse con un déficit neurológico asociado y vasoconstricción multifocal
segmentaria difusa cerebral con resolución espontánea en 3 meses, atribuible a
alteración en la regulación del tono arterial cerebral. Se comentará una serie
de 3 pacientes con diagnóstico de SVCR en nuestro hospital.
Serie de casos: Femenina de 46 años, ingresa por cefalea
occipital de 7 días de evolución asociado a desorientación temporo-espacial,
refractaria a sumatriptán. Agrega a las 48 hs HIP izquierdo, HSA
frontoparietotemporal izquierda con angiografía con reducción de calibre de
ambas arterias cerebrales posteriores y del segmento M1 derecho (Imagen 1).
Masculino de 47 años, ingresa por afasia de 5
horas de evolución. Resonancia con HSA focal temporal izquierda + área de
restricción cortical adyacente (Tabla 1). En nueva RMN por cefalea aparición de
múltiples nuevos focos bilaterales con predominio izquierdo.
Paciente Femenina de 71 años, ingresa por
convulsión tónica clónica generalizada, con TC y RMN con HSA focal de la
convexidad (Tabla 1). Presenta nuevo evento comicial tónico clónico
generalizado con restitución ad integrum.
Discusión: El SVCR está caracterizado por cefalea en estallido
que puede estar asociado o no a síntomas neurológicos o convulsiones en menor
frecuencia, generalmente desencadenado por un gatillo, como presentaron
nuestros pacientes
En los 3 casos los hallazgos imagenológicos
fueron compatibles con SVCR, aunque no en todos se encontró evidencias de
vasoconstricción en el estudio vascular. Sin embargo, es importante tener
presente que la angiografía puede presentar resultados negativos en fases
iniciales o muy tardías.
Respecto al tratamiento, hasta la fecha no se
han realizado ensayos randomizados al respecto. Actualmente consiste en retirar
los desencadenante, manejo analgesico, de presión arterial y nimodipina hasta
cese de la cefalea.
Conclusión: El SVCR es una entidad que requiere una
evaluación cuidadosa de la clínica e imágenes ya que presenta superposición con
otras patologías, pero es caracterizada por ser autolimitada con un buen
pronóstico a largo plazo. Es importante establecer el diagnóstico de SVCR desde
las fases tempranas, ya que el tratamiento puede modificar el curso de estas
enfermedades.


M Gonzalez(1), JE
Alfonso(1), LJ Ojeda Flores(1), KV Velazco Velazquez(1), LF Solis(1), LB
Costa(1), C Pisarello(1), MA Perez Scetti(1), C Mizdraji(1), LG Huespe(1), S
Lazzeri(1), JC Garcia Roth(1), H Alvarez(1)
(1) Hospital Escuela Jose Francisco De San
Martin.
Introducción: La hiponatremia es la alteración
electrolítica más comúnmente evidenciada entre los pacientes de cuidados
intensivos, con un impacto en la mortalidad.
Materiales y métodos: Estudio observacional, retrospectivo y
analítico, llevado a cabo durante el período comprendido desde el 01 mayo al 30
junio del 2022. Se incluyeron pacientes > 18 años. El análisis estadístico
se llevó a cabo con el programa SPSS. Se determinó un valor alfa ≤ 0.05 para
significancia estadística.
Resultados: En el período de estudio ingresaron 88
pacientes, de los cuales se incluyeron 66. El sexo masculino representó el
65,15% de los ingresos. La media de edad fue de 46 ± 17 años, APACHE II 16 ± 7.
El 68% de los pacientes ingresaron desde el servicio de Emergencias. La
incidencia de hiponatremia (NA 125 mEq/L), 18,7% presentaron hiponatremia
moderada (124 – 120 mEq/L), y el 18,7% hiponatremia severa (5 días) (p=,154).
La mortalidad general fue del 42,4%. La presencia de hiponatremia leve al
ingreso, se asoció con un aumento de la mortalidad (OR 3.89 IC95% 0.9-16.6) (p=,055).
Discusión: Nuestro estudio evidenció que un tercio de
los ingresos en terapia presentaron hiponatremia con un impacto en la
mortalidad.
Conclusión: Durante el período de estudio el 24,2%
presentó hiponatremia a su ingreso, asociándose la misma con un aumento del
riesgo en la mortalidad.
AE Garrido(1), AE
Piacenza(1), TC Navarro Toffaletti(1), CB Lopez(1), FN Falcon(1)
(1) Instituto De Cardiología De Corrientes
Juana Francisca Cabral.
Introducción: Los adultos con cardiopatías congénitas
(CCA), constituyen un grupo de alto riesgo de evolución desfavorable ante la
infección por Covid-19.
Objetivo: Reporte de caso clínico de Insuficiencia
respiratoria grave por neumonía por COVID-19 en un paciente con CIV, tratado
con estrategias no invasivas.
Presentación del caso: Paciente de 43 años, portador de CIV. Refiere
iniciar el 13/04/2021 con fiebre, tos y disnea CFII. El día 17/04/2021 test
rápido SARS-CoV-2 positivo, por lo que realiza aislamiento domiciliario.
Progresa a disnea clase funcional III consultando y siendo derivado al servicio
de clínica del Hospital de Campaña. El día 24/04/2021 PCR NO DETECTABLE. El
26/04/2021 Evoluciona con desaturación de 86% con aumentos de requerimientos de
oxígeno (15 l/m).
El 27/04/2021 ingresa al instituto de
cardiología por neumonía por COVID-19 y CIV. Al ingreso Glasgow 15/15, franca
dificultad respiratoria e hipoxemia. En tomografía de tórax infiltrados
alveolares y áreas de consolidación en lóbulo superior, inferior y segmento de
la língula. Se considera la necesidad de IOT. Sin embargo, se decide iniciar
soporte respiratorio con cánula de alto flujo a 50Lts, FiO2 40%, 37°C;
obteniéndose mejoría gasométrica (saturación 93 a 95%). Se alterna con periodos
de VNI (PSV) de 1hs de duración.
El 28/04/21 se inician sesiones de decúbito
prono por presentar PAFI < 150. Ecografía Doppler cardiaca evidencia a nivel
del septum interventricular jet de comunicación restrictivo con QP/QS DE 1. El
paciente continuo con sesiones de decúbito prono y CNAF durante una semana,
evidenciándose mejoría clínica y gasométrica (PAFI 224) por lo que el día
5/5/2021 pasa a sala general.
Conclusión: el uso de alternativas no invasivas de
soporte respiratorio represento una estrategia útil y efectiva en el manejo de
la insuficiencia respiratoria grave por Covid-19.
Discusión: Entre la oxigenoterapia convencional y la
ventilacion invasiva existe un espectro de opciones para el manejo del fallo
respiratorio, que combinadas, pueden resultar útiles y efectivas. El uso de
CNAF y VNI han demostrado disminuir sensiblemente la necesidad de IOT y por
ende la mortalidad.

JA Murtula
Ferreyra(1), S Bernthal(1), J Bartoli(1), M Heredia(1), F Alvarez(1), M
Guereschi(1), A Muhlberger(1), G Martini(1), L Castillo(1), P Diaz(1), S
Julia(1), D Morales(1), F Dominchin(1), A Barcelo(1)
(1) Clinica Universitaria Reina Fabiola.
Introducción: EMAD es una enfermedad inflamatoria,
desmielinizante, focal o multifocal, de sustancia blanca del encéfalo y médula
espinal, de curso agudo/subagudo, usual resolución gradual y base autoinmune.
Generalmente monofásica y etiología poco clara. Aparece tras procesos
infecciosos, colagenopatías o vacunas, más usual en la infancia. Su diagnóstico
es clínico-imagenológico / anatomopatológico y por exclusión.
El objetivo es presentar un paciente adulto
con curso letal asociado a inmunización e infección por SARS-CoV-2.
Presentación del caso: Hombre de 51 años, médico, sin APP
relevantes, que tras la vacunación contra COVID19 presenta síntomas
inespecíficos: astenia marcada y cefalea. Un mes más tarde presentó enfermedad
COVID-19 leve. Al mes tras el alta comienza con disartria y paresia del
hemicuerpo izquierdo. Una IRM-cerebral muestra lesiones de sustancia blanca con
edema y múltiples nódulos con realce de gadolinio; sospecha de EMAD.
Resultados negativos de: panel inmunológico,
serologías, Filmarray-LCR, Ac. antimog, AQP4, pancultivos.
Se realiza pulso de Metilprednisolona 1gx5
sin respuesta. Tres semanas después empeora su foco. Se repiten pulsos de MP
1gx3 + Inmunoglobulinas dosis total 170 g + Rituximab 1gx2 + Plasmaféresis. Un
mes más tarde reingresa por bilateralización de los síntomas. Una biopsia
cerebral revela hallazgos compatibles con EMAD necrohemorrágica. Recibe nuevo
pulso de corticoides y Ciclofosfamida. Presenta mala evolución, cuadriplejia
flácida hiperreflectica, disfagia, disartria, con conservación de la
conciencia. Falleció a tres meses del inicio de los síntomas.
Discusión: Más del 80% de víctimas de EMAD son menores
de diez años y raramente ataca adultos, por lo que debieron descartarse
tumores, enfermedades metabólicas, tóxicas, vasculitis, Enf. desmielinizantes.
El tratamiento dirigido a detener la respuesta autoinmune no detuvo el avance
de la enfermedad. Conocer los mecanismo inmuno-moleculares de esta afección
podría conducir a nuevos tratamientos.
Conclusión: Presentamos un caso de EMAD, refractaria a
tratamiento, con evolución rápidamente progresiva y fatal, que fue un desafío
para el equipo médico. Las lesiones en IRM, la evolución clínica y la biopsia
de cerebro son compatibles con el diagnóstico.
El antecedente vacunal y de enfermedad
COVID-19 orientan a la asociación con EMAD.


0162 IMPLEMENTACIÓN SISTEMÁTICA DE LA DETECCIÓN DE
DELIRIUM EN UNA UCIP A TRAVÉS DE ESCALAS VALIDADAS
C Berrondo(1), C
Laplaza(1), J Caridi(1), R Martínez(1), L Viterbo(1), L Faure(1), J
Salvatierra(1), R Pasmiño(1), E Barlassina(1), D Mujica(1)
(1) De Niños R. Gutiérrez.
Introducción: El delirium es una disfunción cerebral
frecuente en las Unidades de Cuidados Intensivos y asociado a más tiempo en
asistencia ventilatoria mecánica (AVM), de estadía en UCI y hospitalaria, mayor
mortalidad, aumento de los costos, stress post traumático y deterioro cognitivo
a largo plazo. El diagnóstico se realiza por escalas al lado de la cama del
paciente. En esta implementación se utilizaron las escalas psCAM-ICU, pCAM-ICU
y CAPD para detectar sistemáticamente el delirium en los pacientes internados
en una Unidad de Cuidados Intensivos Pediátricos (UCIP).
Objetivo: Describir la implementación de la detección
sistemática de delirium en los pacientes internados en UCIP a través de escalas
validadas.
Materiales y métodos: Diseño: estudio observacional prospectivo
descriptivo de una cohorte.
Ámbito: UCIP polivalente de 18 camas de un
hospital pediátrico de alta complejidad.
Población: todos los pacientes admitidos a la
UCIP por más de 24 hs.
Instrumento: escalas psCAM-ICU, pCAM-ICU y
CAPD. Una evaluación diaria.
Recolección de datos: se registraron
prospectivamente: edad, peso, RASS, soporte ventilatorio, presencia de
delirium, tipo, drogas sedantes, analgésicas, bloqueantes neuromusculares.
Análisis estadístico: Indicadores de proceso: % Promedio de
Pacientes evaluados diariamente: pacientes evaluados / pacientes totales x 100.
% Promedio de pacientes perdidos: pacientes
no evaluados / pacientes internados x 100.
% Promedio pacientes no evaluables (NE):
pacientes NE / pacientes evaluados x 100.
Indicador de resultado: % Pacientes con
delirium: pacientes con escala positiva / pacientes evaluados x 100.
Resultados: Se internaron 340 pacientes en 7 meses de
estudio. Se evaluaron 298 pacientes (42 pacientes perdidos). Se observó disminución
de la pérdida de pacientes con el tiempo (28% inicial – 11% final). Las
evaluaciones diarias fueron en aumento (62% inicial – 87% final) lo que mostró
una adherencia creciente, con un 80% en los últimos 3 meses.
Se observó delirium en 22 pacientes (7.3%),
23% hiperactivos, 36% hipoactivos y 41% mixtos. 77% de los pacientes con
delirium tuvieron menos de 5 años (65% <2 años). 40% no se pudieron evaluar
por RASS profundo o deterioro neurológico severo. 54% presentaron delirium
inmediatamente después del despertar. 45% tenían infusión endovenosa de
opioides y benzodiacepinas.
Conclusiones: La implementación de detección sistemática
del delirium en UCIP es factible. Permite también cuestionarse las prácticas de
analgosedación y el exceso de sedación profunda. La detección sistemática
disminuye el subdiagnóstico y puede mejorar el pronóstico de los pacientes.


G Plotnikow(1), FJ
Bianchini(1), RS Moracci(2), FJ Gutierrez(1), JA Santana Mackinlay(1), F
Melgarejo(1), MP Loustau(1), V Acevedo(1), E Di Salvo(1), J Mariani(1)
(1) Hospital Británico De Bs As. (2) Sanatorio
Anchorena Recoleta.
Introducción: La terapia con oxígeno a alto flujo a través
de cánulas nasales (CNAFO2) consiste en la entrega oxígeno (O2) humidificado y
calentado a alto flujo (hasta 100 Lts/m) controlando la fracción inspirada de
O2 (FiO2). La fracción de acortamiento diafragmática se correlaciona con el
esfuerzo inspiratorio, y la ultrasonografía demostró ser una herramienta válida
y no invasiva para medirla. Por lo tanto, nuestro objetivo fue evaluar el
impacto de la implementación de CNAFO2 sobre la fracción de acortamiento
diafragmático mensurada a través de la ultrasonografía muscular en sujetos
sanos ventilando espontáneamente.
Métodos: Estudio de cohorte, prospectivo, descriptivo
que se realizó en un hospital de la Ciudad Autónoma de Bs As, en el periodo de
tiempo comprendido entre el 1º de marzo al 30 de junio del 2022. Se incluyeron
13 voluntarios sanos, a los cuales se les implementó CNAFO2 y se les midió la
función diafragmática a través de ultrasonografía muscular.
Resultados: La mediana de fracción de acortamiento del
diafragma disminuyó significativamente a medida que el flujo aumentaba
(p<0.05). La medición basal fue de 21.4 (RIQ 17.4-30) % sin CNAFO2, de 18.3
(RIQ 13-23.1) % con CNAFO2 a 20 L/m y de 16.4 (RIQ 11.7-27.5) % con CNAFO2 a 40
L/m (Figura 1). Observamos también una disminución significativa de la
frecuencia respiratoria (FR) a medida que aumentaba el flujo en la CNAFO2
(p<0.05), a razón de 1 ciclo cada 4 L/m administrados. La mediana de FR
basal fue de 16 rpm (RIQ 14-18), con 20 l/m tenían una mediana de 10 rpm (RIQ
8-12) y a 40 l/m de flujo los pacientes tenían una mediana de 6 rpm (RIQ 6-7)
(Figura 2).
Conclusiones: La utilización de oxigenoterapia de alto
flujo en sujetos sanos disminuye la fracción de acortamiento diafragmático y la
frecuencia respiratoria conforme aumenta el flujo utilizado. Esto podría
fundamentar el uso de flujos elevados aun en situaciones de normoxemia.


JM Nuñez
Silveira(1), VR Ruiz(2), LN Borrajo(2), EM Steinberg(2), I Ceballos(2), J
Ems(2), N Roux(2)
(1) Hospita Italiano. (2) Hospital Italiano
De Buenos Aires.
Introducción: El trasplante pulmonar es el tratamiento de
elección en la etapa terminal de enfermedades pulmonares. A través de TIE se
logra ver la distribución de los volúmenes pulmonares, constantes de tiempo,
índices de inhomogeneidad y espacios silentes de manera no invasiva. De igual
manera con el uso de ultrasonografía es posible observar directamente la
capacidad de contracción del diafragma y el trofismo.
Presentación del caso: Ingresa a UTI en postoperatorio de trasplante
unipulmonar, se observa a través de TC, una menor expansión del hemitórax
izquierdo e hiperinsuflación aguda (HA) del pulmón nativo. Se programó
traqueostomía, al día 6. Día 9 se conecta a ECMO V-V. Día 18 se retira el ECMO.
Día 20 comienza PVE en tubo en T con oxígeno. Luego de intentos fallidos de PVE
se realiza mediciones avanzadas.
T0 en PC-CSV 7 cmH2O, PEEP de 5 cmH2O, FiO2 de
30%, 15 minutos. Se toma 10 minutos de vuelta a la situación basal. T1, 15
minutos en CPAP 5 cmH2O, FiO2 30%. T2, 15 minutos en tubo en T oxígeno de 3
l/m.
Discusión: En el caso presentado, se observa a través de
la ultrasonografía una función asimétrica del diafragma, al igual que en el
trabajo del grupo de Troyer et, al.
La medición del TIE arrojó un índice de
inhomogeneidad elevado, lo que manifiesta las diferencias en la distribución
del volumen, que a su vez provoca constantes de tiempo sumamente diferentes.
Además, se observa un atrapamiento aéreo en las curvas donde se discriminan los
cambios de impedancia de cada pulmón durante los ciclos sucesivos
Las mediciones de P.01 y Pocc reflejaron
valores que no se asocian con aumento significativo de la presión muscular o el
drive central, lo que no fue concluyente a la hora de identificar la causa de
falla de la desvinculación en el paciente.
Conclusión: Las herramientas de monitoreo avanzado
podrían orientar el diagnóstico de la causas del fracaso en el destete de la
ventilación mecánica en pacientes con trasplante unipulmonar. Se requieren más
estudios para determinar la utilidad clínica de estas herramientas en el
destete de la ventilación mecánica invasiva.
0165 Reporte de un caso de Mal de Pott en un
lactante
L Menta(1), E
Paz(1), A Coca Salazar(1), A Dalzotto(1), C Olivera(1), C Karina(1)
(1) Hospital El Cruce.
Introducción: La tuberculosis (TB) continúa siendo un grave
problema de salud pública, siendo una de las principales causas infecciosas de
muerte.
Las manifestaciones extrapulmonares se
presentan entre el 10 al 15 % y el compromiso músculo esquelético en 10 al 20%
. La localización más común musculoesquelética es en columna 50 % (enfermedad
de Pott).
Caso clínico: Varón de 2 meses previamente sano ingresa con
diagnóstico de invaginacion intestinal y sepsis. Evoluciona con cuadro de
dificultad respiratoria que requiere asistencia ventilatoria mecánica (AVM). La
radiografía de tórax evidencia derrame pleural izquierdo y lesión vertebral. En
líquido pleural aisló Stafilococo Aureus meticilino sensible(SAMS). La
evolución fue tórpida requiriendo estudios complementarios.
La Resonancia magnética nuclear (RMN) de
columna muestra acuñamiento anterior de vértebras D6 y D8 con desplazamiento
posterior de D7 e irregularidad de los contornos de los cuerpos vertebrales y
compromiso de discos intervertebrales con cambios en las partes blandas
contiguas, colección líquida epidural antero-posterior que realza el anillo
tras la administración de gadolinio compatible con proceso infeccioso (figura
1).
Debido a que los hallazgos en las imágenes
sugieren Enfermedad de Pott se inició tratamiento con Tuberculostáticos y
continuó con cefalotina.
Se realizó aspirado gástrico y traqueal para
BAAR que fueron negativos, se tomó muestra por punción-aspiración de zona
vertebral guiada donde rescata Mycobacterium Marselliense.
Discusión: Dada la complejidad del caso, compromiso óseo
con destrucción de varios cuerpos vertebrales, posibilidad de complicaciones
motoras graves y edad del niño, se realizó Ateneo multidisciplinario
decidiendose descompresión quirúrgica del canal medular y fijación de la
columna con homoinjerto óseo e inmovilización con corsé tipo Minerva. En un
segundo tiempo se realizará evaluación y se determinará la necesidad de nueva
cirugía.
Un distractor que generó duda en el caso fue
el aislamiento del SAMS ya que se describen lesiones compatibles por dicho
germen similares a las halladas.
Conclusiones: El diagnóstico de tuberculosis extrapulmonar
representa un desafío debido a que las muestras son paucibacilares por lo que
se requiere un alto índice de sospecha y una exhaustiva historia clínica. Las
complicaciones de la enfermedad son devastadoras e incluyen destrucción ósea,
deformidad de la columna y disfunción neurológica severa.

0166 USO DE ACIDO TRANEXAMICO
EN PACIENTE CON ENFERMEDAD DE VON WILLEBRAND CON SHOCK HEMORRAGICO
A Gira(1), F
Leveratto(1), V Pousa(1), A Riios(1), P Pratesi(1)
(1) Universitario Austral.
Introducción: Enfermedad de Von Willebrand (EVW) es la
coagulopatia hereditaria más frecuente, el factor de Von Willebrand (FVW) media
la adhesión plaquetaria al factor VIII para formar el coagulo de fibrina.
Existe mayor prevalencia de hemorragia en EVW
vs personas sanas, en Metrorragia 90% vs 25%, en hemorragia 45% vs 20%.
El tratamiento incluye Desmopresina: aumenta
3 -5 veces los valores de FVIII Y FVW 0,2 ug /K , Hemate P: concentrados
inactivados de FVIII y FVW , Acido tranexamico: 15 mg/k cada 8 hs,
antifibrinolitico, inhibidor del plasminogeno y plasmina, usado para
tratamiento y profilaxis de sangrado en hiperfibrinolisis.
Reporte de caso: Mujer de 39 años, antendecentes de EVW ,
Gesta 10, P7, A3.
Ingresa por guardia por metrorragia posterior
a ingesta de Misoprostol por embarazo detenido y retenido de 11 semanas. Al
ingreso taquiardica y taquipneica, Hemoglobina baja, coagulograma y
Tromboelastograma normal, Hematologia indica Desmopresina 18 mcg, crioprecipitados
y 1 gr de ácido tramexamico, se realiza legrado requiere 2 UGRS, vasopresores,
continua con acido tranexamico 1 gr cada 8 hs por 72 hs. Posterior a 5 dias en
UCI pasa a clínica médica.
Discusión: La hiperfibrinolisis es frecuente en trauma y
hemorragia ginecobstericas severa. Se recomienda Acido tranexamico como
profilaxis en EVW en situaciones con riesgo de hiperfibrinolisis como cirugías
programadas odontológicas y ginecoobstericas. En nuestro caso no se usó como
profilaxis solo como tratamiento.
Conclusión: Considerar el uso de drogas
antifibrinoliticas como el acido tranexamico en Enfermedad de Von Wllibrand ya
que reduce el riesgo de hemorragia y muerte materna
0168 Hantavirus: reporte de un
caso
MM Palacio(1), CA
Eckhard Morales(2), E Avila(3)
(1) Kirchner. (2) Angel C.padilla. (3)
Maternidad.
Introducción: La infección por hantavirus produce
enfermedades zoonóticas con una tasa de mortalidad de hasta un 60%, no
existiendo un tratamiento específico y cuyo diagnóstico temprano puede reducir
la mortalidad a la mitad. El reservorio del virus que pertenece a la familia
Bunyaviridae y del cual se conocen aproximadamente 50 tipos diferentes, se
encuentra en roedores cola larga o del campo, y al parecer cada tipo de virus se
relaciona con determinado roedor. Causan dos tipos diferentes de enfermedad una
con repercusión pulmonar que es la que prevalece en América y otra fiebre
hemorrágica y síndrome renal endémica en Europa y Asia. En la provincia de
Tucumán no existen casos frecuentes, ni es considerada zona endémica si bien el
roedor reservorio está presente.
Caso clínico: Paciente de sexo masculino de 39 años,
trabajador rural, que ingresa a terapia intensiva con síndrome febril
artralgias y mialgias de 1 semana de evolución, dolor abdominal, náuseas y
vómitos, oliguria y deshidratación, evoluciona en 48 horas con insuficiencia
respiratoria, tac de tórax con infiltrado de aspecto alveolar de localización
hiliar y parahiliar bilateral, gasométria de síndrome de distress respiratorio
grave, requiere de asistencia respiratoria mecánica. Evoluciona con Shock
hipovolémico monitorizado por ultrasonografia de la vena cava inferior.
hemoconcentración por laboratorio, intercurre con fracaso renal agudo anuria
requiriendo hemodiálisis. Se toman muestras para serologías hanta-virus,
leptospira, influenza, sarscov2, Informándose Elisa positivo hantavirus.
Evolución clínica favorable, desvinculada de ARM al quinto día, y suspensión de
hemodiálisis al dia 9.
Conclusión: La provincia de Tucumán no reporta casos
frecuentes de Hanta Virus, el cuadro clínico puede ser subestimado por su
similitud con otros procesos febriles respiratorios. El diagnóstico temprano y
tratamiento dirigido disminuye la mortalidad.




0169 VASOESPASMO POST CIRUGÍA
DE RESECCIÓN DE ADENOMA HIPOFISARIO: PRESENTACIÓN DE UN CASO.
S Schverdfinger(1), C
Videla(1), N Ciarrocchi(2), J Sinner(1)
(1) Hospital Italiano De Buenos Aires. (2)
Hospital Itailano De Buenos Aires.
Introducción: El vasoespasmo postquirúrgico es un hallazgo
poco frecuente (1,9%) pero con una morbimortalidad elevada, en parte por la
falta de reconocimiento de dicha entidad a tiempo. Principalmente se visualiza
en postoperatorios de tumores hipofisarios y de meningiomas, presentándose
entre el 4 y 7mo día de la cirugía a predominio de la circulación anterior.
Presentamos un caso de vasoespasmo temprano
post resección de adenoma hipofisario con mala evolución clínica.
Presentación del caso: Paciente masculino de 47 años, sin antecedentes
relevantes, que se interna de forma programada para resección de adenoma
hipofisario cuya clínica era alteración del campo visual.
En las 24 horas posteriores al procedimiento
comienza con somnolencia por lo que se realiza tomografía de cerebro evidenciándose
HSA supra e infratentorial asociada a volcado ventricular (Imagen 1).
Evoluciona con paresia facio-braquio-crural derecha por lo que se realiza
angiotomografía de cerebro evidenciándose disminución del calibre difuso de los
vasos intracraneanos a predominio del circuito anterior, interpretándose como
vasoespasmo moderado/severo (imagen 2). Se realiza tratamiento médico con
nimodipina e hipertensión arterial con evolución desfavorable por lo que se
realiza angiografía para tratamiento farmacológico y endovascular del
vasoespasmo.
A pesar del tratamiento instaurado intercurre
con edema cerebral difuso secundario a isquemias difusas en tomografías
sucesivas, con hipertensión endocraneana refractaria al tratamiento médico
realizando en última instancia una craniectomía descompresiva. Intercurre con
elevación sostenida de la presión intracraneana con cuadro clínico compatible
con muerte encefálica.
Discusión: El vasoespasmo postquirúrgico es una
complicación poco frecuente pero con elevada morbimortalidad. Dentro de los
factores predisponentes se encuentra la localización de tumor, la invasión
tumoral de la vasculatura, la estirpe tumoral y su vascularización, la HSA
postquirúrgica, la disfunción hipotalámica y meningitis postoperatorio, entre
otros. El tratamiento consiste en el uso de nimodipina, hipertensión arterial y
como última instancia tratamiento endovascular farmacológico o angioplastia,
sin una clara evidencia.
Presentamos un paciente con vasoespasmo
severo postoperatorio refractario al tratamiento instaurado, tanto médico como
quirúrgico, con evolución a muerte encefálica.
Conclusión: El vasoespasmo postoperatorio sin bien es
poco frecuente, genera una alta morbimortalidad por lo que consideramos
fundamental su diagnóstico precoz para efectuar el monitoreo y tratamiento
adecuado.


MA Alzugaray, S
Izza(1), M Filippi(1), N Carrizo(1), R Avila(1)
(1) Hospital José Maria Cullen.
Introducción: La hipertrigliceridemia (HTG) es la tercer
causa de pancreatitis aguda (PA). Con un valor de corte de triglicéridos (TG)
superior a 1000 mg/dl. Representa el 4–10% de los casos, con una
morbimortalidad mayor al 30%. El tratamiento incluye restricción dietética,
administración de hipolipemiantes, insulina y heparina. La plasmaféresis se ha
propuesto como otra alternativa terapéutica, aunque disponible en pocos
centros.
Caso clínico: Paciente
masculino de 28 años, con antecedente de obesidad mórbida y diabetes mellitus,
consulta por dolor abdominal y vómitos. Laboratorio: TG 11.200 mg/dl,
amilasemia 470 U/L, glucemia 2,6 g/l, acidosis metabólica, cetonemia positiva.
Tac de abdomen: Baltazar B. Se interpreta como Pancreatitis aguda grave
secundaria a hipertrigliceridemia, asociada a cetoacidosis diabética. A pesar
de la reanimación inicial y el tratamiento estándar, persiste con dislipemia
severa y SOFA elevado, por lo que se decide iniciar plasmaféresis (recambio plasmático
por filtración, maquina Amplya). Se realizaron tres sesiones con buena
evolución y descenso de los triglicéridos (luego de la primera sesión descendió
a 500 mg/dl). Continuó con tratamiento médico e hipolipemiantes hasta el alta.
Discusión: La plasmaféresis extrae lipoproteínas de baja
densidad con sustitución de un coloide (albumina y/o plasma), reduce los
niveles de TG y de citoquinas inflamatorias; de esta manera lograría un rápido
descenso de triglicéridos desde la primera sesión.
La evidencia muestra que son suficientes de 1
a 3 sesiones para mejorar la condición clínica y reducir el riesgo de
recurrencia. Grado de recomendación de la ASFA (1C).
Ante la falta de respuesta con la terapéutica
estándar en cuanto a complicaciones sistémicas, locales y mortalidad, algunos
autores recomiendan el empleo de este método de depuración extracorpórea.
Conclusión: En nuestro caso, la plasmaféresis redujo
rápida y significativamente el valor de triglicéridos y llevó a la mejoría
clínica.
Este procedimiento extracorpóreo no está
disponible en muchos centros, y su reporte para el tratamiento de pancreatitis
hipertrigliceridémica es muy bajo en nuestro país.
I González(1), CB
Dominguez(1), EA Di Salvo(1), MP Loustau(1), VS Acevedo(1), JC Melero(1), MD
Celano(1), FJ Bianchini(1), FJ Gutierrez(1), J Mariani(1), G Murias(1), GA
Plotnikow(1)
(1) Hospital Británico De Bs As.
Introducción: Las principales funciones del balón de
neumotaponamiento del tubo endotraqueal (TET) son evitar la macroaspiración y
permitir la presurización del sistema respiratorio. Para esto es fundamental
mantener una adecuada presión dentro del balón disminuyendo así los riesgos
para el paciente. Su control rutinario con el manovacuómetro se considera la
mejor alternativa.
Objetivo: Evaluar el comportamiento de la
presión del balón de neumotaponamiento de diferentes TET durante la simulación
de una maniobra de insuflado y control de la misma con diferentes
manovacuómetros.
Materiales y Métodos: Se realizó un estudio analítico, de cohorte y
transversal. Se emplearon 4 marcas de TET de un lumen tipo Murphy de 8 mm de
diámetro interno con balón y 3 modelos de manovacuómetros. Además, se utilizó
un monitor de mecánica respiratoria (Fluxmed® MBMed) conectado al interior de
balón a través del cuerpo del extremo distal del TET. La secuencia de medición incluyó
cinco presiones (Figura 1).
Resultados: Se realizaron un total de 528 mediciones
sobre los 4 TET. Durante el procedimiento completo (conexión y desconexión) se
observó una caída significativa de la presión de 6,98 ± 1,39 cmH
2O con respecto a la presión inicial (P
INICIAL) (p<0,05). De la cual, 6,01 ± 1,36 cmH2O se perdieron durante la
conexión (diferencia entre P INICIAL y P CONEXION). El valor de P RECONEXIÓN
fue de 19,1 ± 1,64 cmH2O, lo cual evidencia una caída total significativa de la
presión de 10,9 ± 1,64 cmH2O (diferencia entre P INICIAL y P
RECONEXION) (p<0,05). Por último, la media
de PFINAL fue 29,6 ± 1,34 cmH2O.
Los distintos manovacuómetros mostraron
diferencias significativas entre sí, de acuerdo al momento de medición
considerado (p<0,05). Un fenómeno similar se evidencio al analizar los
diferentes TET (p<0,05) (Figura 2).
Conclusión: Como consecuencia de la práctica habitual de
medición de la presión del balón de neumotaponamiento se producen
modificaciones importantes, que pueden influir en la seguridad del paciente.


0174 TUBERCULOSIS EXTRAPULMONAR
EN LA TERAPIA INTENSIVA INFANTIL. REPORTE DE CASOS
M Pazmino(1), M
Gonzalez(1), P Castellani(1), C Lutkevicius(1), A Bordogna(1), M Rabino(1)
(1) Especializado En Pediatría Sor María
Ludovica De La Plata.
Introducción: La tuberculosis (TBc) es un problema de salud
pública con mayor incidencia en los últimos años, la morbimortalidad ocasionada
puede generar importantes complicaciones y potenciales secuelas. Su magnitud de
epidemia está subestimada sin manifestaciones clínicas específicas, lo que
retrasa el tratamiento y eleva el riesgo de infección diseminada. La mayoría de
los casos son de localización pulmonar, cercanas al 20% son extrapulmonar.
Objetivos: Describir las características clínicas y
secuelas de una serie de pacientes con Tbc extrapulmonar que requirieron Unidad
de Cuidados Intensivos Pediátricos (UCIP) durante el período 2020 a 2022.
Descripción: Se reportan
cuatro casos de pacientes con promedio de edad de 20 meses, sin predominio por
el sexo, con promedio de 5 días desde el inicio de los síntomas hasta el
ingreso a UCIP, la causa de ingreso fue deterioro del sensorio, requirieron ARM
alrededor 20 días, todos tenían la vacuna BCG. Las variantes clínicas dependen
del sistema comprometido, Meningitis en 3 casos debutaron con rigidez cervical
y deterioro neurológico, otro con compromiso intestinal presentó inicialmente
síntomas gastrointestinales.
No se tuvo rescate microbiológico en 2 de los
4 pacientes, se trataron por la presentación clínica y epidemiología positiva
en catastro familiar; un solo paciente el Genexpert positivo, y un solo caso
tuvo infección diseminada. Todos recibieron levofloxacina adicional a las
drogas de primera línea Isoniacida, pirazinamida, etambutol y rifampicina
durante la fase de inducción debido a llegada dificultosa a SNC, y aquel con
compromiso intestinal Amikacina, Meropenem y Rifampicina hasta la
rehabilitación enteral. Las secuelas neurológicas fueron síndrome pierde sal
cerebral, cuadriparesia espástica, hidrocefalia con requerimiento de VDVP, dos
fallecieron por otras causas; y se visualizó perforaciones intestinales y
abscesos interasas que condicionó yeyunostomía y nutrición parenteral durante 6
meses, hasta rehabilitación enteral.
Conclusiones: La causa de ingreso a UCIP de pacientes con
TBc son SDRA, falla multiorgánica, estatus convulsivo, deterioro neurológico.
La sospecha clínica es un reto para llegar al diagnóstico debido a la baja
especificidad de los síntomas, la dificultad para obtener muestras adecuadas y
bajo reporte epidemiológico lo que conlleva al retraso en el diagnóstico y
tratamiento, incrementado el riesgo de infección diseminada grave.


DP Acosta(1), D
Vazquez(1), N Fermin Paredes(1), W Rosales(1), C Bernal(1), S Eiguren(1), L
Bucetta(1)
(1) Sanatorio Anchorena.
Objetivo: Evaluar el valor predictivo de parámetros de
shock oculto como exceso de base (EB) <-2, Tiempo de Relleno Capilar
(TRC)>3 segundos y Lactato >20 mg/dL, para predecir el desarrollo de
shock séptico en pacientes ingresados a UTI con sospecha de infección.
Materiales y métodos: Estudio de cohorte prospectiva. Población:
adultos que ingresan a UTI con sospecha de infección definida por toma de
hemocultivos y/o inicio de antibióticos entre 02/06/2022 al 06/08/2022.
Resultados: Ingresaron 40 pacientes de los cuales,
20(50%) evolucionaron a shock séptico.
Al ingreso (0 h), 28 pacientes (70%)
presentaron EB<-2, con un valor de –4,6[-1.45- -7,6], 18(45%) un TRC >3s
y 17(42,5%) lactato de 16,8[12-31] mg/dl. Los controles a las 6h fueron:
27(67%) con EB –5[-0,8- -8,3], TRC > 3s 15(37,5%) y 19 pacientes (47%) con
lactato de 19,7[13,6-35,8]. A las 12 hs, 26(65%) presentaron EB de –4,7[-1,2-
-7,6], TRC >3s 12(30%) y 13(32%) lactato de 19,3[14-23,3]. A las 24 hs,
23(57%) pacientes EB –5[-1,2- -7,8], TRC > 3s 7(17,5%) y 13(32%) con lactato
de 18.9 [13,9-30.3].
Recibieron resucitación con cristaloides (1,5
[0,5-2,75]), vasoactivos 10(44%), ARM 18(45%) y hemodiálisis de urgencia
5(12,5%). El tiempo de estadía en UTI fue de 7[3-16] días. La mortalidad fue
del 25% (10).
En el análisis multivariado, el TRC al
ingreso se relacionó independientemente con el desarrollo de shock séptico (OR
10,1 [1,67- 61,4] p 0.012) mientras que el valor de lactato a las 6 hs, no lo
fue (OR 2,19, [0,43-11,05] p 0.34).
Conclusiones: De los tres parámetros de shock oculto
evaluados en pacientes con sospecha de infección al ingreso a UTI, el TRC fue
el único predictor independiente de desarrollo de shock séptico. Los pacientes
con sospecha de infección que fallecieron presentaron más frecuentemente un TRC
alterado a las 6h y peores valores de lactato y déficit de base a las 12 horas.
En conclusión, el TRC fue el primer valor en alterarse y el único con valor
predictivo.


DP Acosta(1), D
Vazquez(1), N Fermin Paredes(1), W Rosales(1), C Bernal(1), S Eiguren(1), L
Bucetta(1)
(1) Sanatorio Anchorena.
Objetivo: Evaluar las características y evolución de pacientes
con sospecha de infección que requieren ingreso a UTI.
Materiales y métodos: Estudio de cohorte prospectiva. Población:
adultos que ingresan a UTI con sospecha de infección definida por toma de
hemocultivos y/o inicio de antibióticos entre 02/06/2022 al 06/08/2022.
Resultados: Ingresaron 40 pacientes. 20 (50%)
evolucionaron a shock séptico, de los cuales fallecieron 8 (40%). Sus
características y evolución se detallan en Tabla 1. El tiempo promedio de
inicio de antibióticos fue de 2±1 hs, 18 (45%) requirieron ARM, de los cuales 7
(38%) fallecieron. El tiempo de estadía en UTI fue de 7 [3-16] días. La
mortalidad fue del 25% (10).
Conclusiones: Se trató de una población de pacientes
añosos, la mayoría varones, que ingresaron a UTI por causas médicas, la mayoría
evolucionaron a sepsis y la mitad a shock séptico, requiriendo ARM. La
mortalidad del shock séptico fue menor a la media nacional (SATI Sepsis).


0178 DECÚBITO PRONO PROLONGADO
EN PACIENTES COVID-19 EN VENTILACIÓN
MECÁNICA. ESTUDIO RETROSPECTIVO
MD Celano(1), JC
Melero(1), EA Di Salvo(1), VS Acevedo(1), MP Loustau(1), I González(1), CB
Dominguez(1), FJ Bianchini(1), MR Del Bono(1), I Brozzi(1), GD Garay(1), FJ
Gutierrez(1), G Murias(1), GA Plotnikow(1)
(1) Hospital Británico De Bs As.
Introducción: Existe evidencia a favor del uso del decúbito
prono (DP) en ventilación mecánica (VM) y de los beneficios en relación a la
mortalidad en pacientes con SDRA. Además, algunos reportes afirman que hacerlo
de manera prolongada por periodos mayores a 24 horas es seguro, pero no está
exento de complicaciones. Durante la pandemia por COVID-19 un elevado número de
pacientes requirió DP durante la VM. En Argentina se desconoce las
características de esta población y la prevalencia de lesiones asociadas al
mismo. Por lo tanto, nuestro objetivo principal en este estudio fue describir
la población que requirió DP prolongado durante la VM por falla respiratoria
aguda por COVID-19. Además, describir la presencia de lesiones asociadas al
mismo y determinar los factores de riesgo para el desarrollo de estas.
Materiales y métodos: Se realizó un estudio observacional,
retrospectivo, descriptivo que incluyó pacientes internados en la UCI por
COVID-19, que requirieron VM y DP por un periodo de tiempo ≥ 24 horas de manera
continua. El DP se utilizó en ciclos de 72 horas ininterrumpidas.
Resultados: Ingresaron 155 pacientes, de los cuales, se
analizaron 94 (60,3%) que requirieron DP. La mayoría de género masculino (64%)
con una mediana de edad de 67 [61-74] años, con un APACHE II de 13,4 y en su
mayoría inmunocomprometidos (29%). La estadía en UCI fue significativamente
mayor en los pacientes que requirieron DP (26 [17-38] vs 18 [11-33] días;
p<0.05) como así también los días de VM (22 [14-31] vs 10 [5-24] días; p<0.05).
Los 94 pacientes tuvieron lesión grado I, y 39 (41%) pacientes tuvieron
lesiones graves ≥II. En lo que respecta a las complicaciones, la suspensión de
la alimentación por
desplazamiento de sonda nasogástrica fue el
evento más reportado. (Figura 1). La obesidad y la cantidad de ciclos en DP se
asociaron a la presencia de lesiones graves (p<0.05) (Tabla 1).
Conclusión: Las características de los pacientes COVID-19
en VM que requieren DP no distan mucho de aquellas descriptas para los
pacientes críticos COVID-19 ventilados internados en las UCIs. En estos, la
presencia de úlceras por presión graves fue un evento relativamente frecuente,
en donde la cantidad de ciclos de DP de manera prolongada y la obesidad
aparecieron como factores de riesgo para su desarrollo.


M Baron(1), P
Schoon(1), L Benito(1), N Montaño(1), N Carbajal(1), P Anave(1), P Carrasco(1)
(1) Higa Guemes Haedo.
La tuberculosis es una de las principales
causas de morbi-mortalidad a nivel mundial. Un 20 % tienen presentación extra
pulmonar. El compromiso pericardio en esta enfermedad representa hasta un 4 %.
Sin diagnostico y tratamiento la mortalidad es cercana al 90 %.
Objetivo: Presentación de un caso y revisión de la
literatura.
Presentación del caso: Paciente de 62 años, hipertensa, ingresa con
precordalgia y disnea progresiva de 3 semanas de evolución, al examen físico se
evidencia ruidos cardíacos hipofonéticos, ingurgitación yugular, edema de
miembros inferiores e hipoventilación pulmonar izquierda. Electrocardiograma:
Ritmo sinusal, hipovoltaje QRS en todas las derivaciones. Ecocardiograma:
Derrame pericardio severo con colapso diastólico de cavidades derechas.
Ecopleura: Derrame pleural izquierdo moderado. Toracocentesis: Trasudado.
Cultivo negativo.
Se interna por derrame pleuro-perdicárdico en
estudio, con sospecha de enfermedad oncológica, reumatológica o tuberculosis
extrapulmonar. Perfil reumatológico normal, prueba ELISA para HIV negativa. Se
realiza Ventana pleuro-pericárdica por VATS con toma de biopsias de pleura y
pericardio. Intercurre con FAARV, se realizó cardioversión farmacológica.
Biopsia pleural: Infiltrados inflamatorios crónicos, sin evidencia de B.A.A.R.
Biopsia de pericardio: Infiltrados inflamatorios crónicos, RT-PCR:
Mycobacterium tuberculosis. Se inició tratamiento con drogas de primera línea y
corticoterapia. Mejoría clínica, estable hemodinámicamente, pasa a sala
general. Luego de 1 semana de tratamiento, se evidenció resolución de derrame
pleural y derrame pericárdico. Con buena tolerancia al tratamiento, egreso
hospitalario previo control de Ecografía pleural, sin evidencia de derrame y
Ecocardiograma: Pericardio libre.
Discusión: La presentación clínica de la tuberculosis
pericardica conlleva diagnósticos diferenciales oncológicos y reumatológicos.
La biopsia pericárdica hizo posible un diagnóstico oportuno, a pesar de que la
sospecha inicial apuntaba a patología oncológica. Y se pudo iniciar tratamiento
oportuno. Pacientes con riesgo de exposición en países endémicos que presenten
derrame pericárdico debe sospecharse la etiología tuberculosa.
Conclusión: La pericarditis tuberculosa, manifestación
infrecuente, tiene morbi-mortalidad elevada; con un diagnóstico oportuno y
tratamiento temprano podría obtenerse la resolución del cuadro. Sin embargo, su
diagnóstico es un desafío, dado que la presentación clínica es inespecífica.
Deben combinarse estudios de imagen y microbiológicos asociados a factores
epidemiológicos para su confirmación.

VA Gallardo(1), GV
Limon(1), M Lamas(1), P Balceda(1), G Cruz(1), M Balceda(1), D Crespo(1), C
Tintilay(1), D Sajama(1), C Caceres(1), G Rodriguez(1), N Palacios(1), O
Lopez(1), P Baez(1)
(1) Pablo Soria.
Introducción: La sedación y la analgesia son una práctica
habitual en las Unidad de Terapia Intensiva (UTI) y constituyen parte del
tratamiento del paciente crítico y su uso no está exento de complicaciones,
derivadas en su mayoría de su baja o sobre utilización, que pueden prolongar la
Ventilación Mecánica (VM), complicar la evolución y pronóstico del paciente
crítico e incrementando el coste sanitario. De ahí la importancia del trabajo
de investigación tener como OBJETIVO determinar el nivel de conocimientos y
prácticas de enfermería en la valoración de escalas en pacientes con
sedoanalgesia (SA) sometidos a VM de la UTI, del Hospital Pablo Soria (HPS), de
la provincia de Jujuy.
Materiales y método: Fue observacional, descriptivo de corte
transversal cuantitativo, la muestra estuvo constituida por 40 profesionales de
enfermería, exclusión a jefe de la unidad, instructores, jefa y residentes de
enfermería. El instrumento para recolectar datos un cuestionario cerrado para
determinar el nivel de conocimiento de SA y una planilla observacional de
práctica.
Resultados: En el periodo de 4 meses, se demostró que el
personal de enfermería tiene un nivel de conocimiento en la valoración de
escalas en pacientes con SA sometidos a VM, solo un 5% es alto, un 75% es medio
y un 20% es bajo y en la práctica el 20% tiene práctica adecuada, el 35,5%
aceptable y el 47,5% inadecuada. CONCLUSION se determinó que el conocimiento
del profesional de enfermería es un Conocimiento Medio y práctica inadecuada.


S Sciuto(1), MM
Santini(1), PR Peral(1), FE Villagra(1), EM Arocena(1), JN Martínez Nehin(1), I
Zabert(1), GE Zabert(1)
(1) Clínica Pasteur.
Introducción y objetivos: La internación en una Unidad de Terapia
Intensiva (UTI) genera en hasta la mitad de los pacientes, alteraciones
físicas, cognitivas y psiquiátricas denominadas Síndrome Post Cuidados
Intensivos (SPCI) cuyas secuelas pueden durar hasta un año como se ha reportado
en el SPCI asociado a COVID-19. Objetivo: Describir la evolución dentro de un
centro de rehabilitación (CR) de los sujetos con diagnóstico de SPCI asociado a
la COVID-19 en términos de funcionalidad respiratoria, alteración cognitiva,
independencia en actividades de la vida diaria (AVD) y mortalidad.
Material y métodos: estudio de cohorte retrospectivo que incluyó
adultos con diagnóstico de SPCI asociado a COVID-19 asistidos en un CR
interdisciplinario. Se registraron características clínico-demográficas,
requerimiento de ventilación mecánica (VM) y decúbito prono en UTI, VM y
traqueostomía (TQT) al ingreso y al egreso del CR, fuerza muscular con la
escala Medical Research Council (MRC), capacidad funcional con el Test de
Marcha de 6 minutos (TM6), valoración cognitiva con la escala de Pfeiffer,
nivel de independencia en AVD con el Índice de Barthel (IB), destino al alta y
mortalidad.
Resultados: Se evaluaron 130 sujetos, todos recibieron VM
en centro de agudos. El 66,1% fueron hombres con edad media de 54 años. El 90%
tenía antecedentes patológicos. Al ingreso, 21,5% requerían VM y 74,6% TQT.
Permanecieron una mediana de 37 días en el CR. Al 90,8% se le otorgó el alta
domiciliaria sin VM y 2 con TQT. 5 fallecieron manteniendo la VM y 4 con TQT. 7
fueron derivados, 2 a otro CR y 5 a cuidados agudos por complicaciones, de los
cuales, 2 con TQT, 1 óbito y 4 altas domiciliarias.
La comparación al ingreso y al egreso del
MRC,Pfeiffer e IB resultó estadísticamente significativa (p<0.001). El TM6
al ingreso fue no evaluable y al egreso caminaron una mediana de 355 metros
(IC95% 145-480).
Conclusiones: La internación en un CR para sujetos con SPCI
asociado a COVID19 resultó segura y generó mejoras significativas en fuerza
muscular, capacidad funcional, alteración cognitiva e independencia en las AVD,
logrando 90% alta domiciliaria y 3,85% de mortalidad.


MM Balceda(1), M
Lamas(1), DS Crespo(1), GR Cruz(1), C Caceres(1), N Palacio(1), G Rodriguez(1),
P Baez(1), O Lopez(1), V Gallardo(1), P Balceda(1), V Limon(1), C Tintilay(1),
D Sajama(1)
(1) Pablo Soria.
Introducción: Como todo servicio de Cuidados intensivos, el
personal enfermería de terapia intensiva está expuesto a diferentes factores de
riesgos durante la atención, y en el contexto de pandemia, éstos riesgos no
sólo son físicos sino mentales y ponen a prueba los conocimientos, habilidades,
valores y actitudes de los enfermeros frente a situaciones de elevado estrés
llevando a utilizar distintas estrategias de afrontamiento de protección
mental.
Objetivo: La presente investigación tuvo como objetivo
general Determinar las estrategias de afrontamiento para proteger la salud
mental ante el Covid-19 que utiliza el personal de enfermería de la terapia
intensiva del Hospital Pablo Soria, de la Ciudad de San Salvador de Jujuy,
durante el 3er trimestre del 2021, se tomó como referentes teóricos a
Frydenberg y Lewis (1993 en Canessa, 2002), quienes presentan tres estilos de
afrontamiento: Resolución de problemas, Referencia a otros y Afrontamiento no
productivo. Este estudio fue de utilidad para detectar o prevenir signos o
síntomas que llevan a desequilibrios psicológicos, emocionales o mentales que
ineludiblemente interfieren o influyen en la calidad de atención brindada a las
personas que están en riesgo de perder su integridad física o en última
instancia, su propia vida.
Materiales y método: Tipo de estudio descriptivo y transversal.
Variable: Estrategias de afrontamiento. Dimensiones: Resolución de problemas,
Referencia a otros y Afrontamiento no productivo. Universo: 40 profesionales
enfermeros. Tiempo: 3er trimestre del 2021. Fuente: primaria. Técnica de
recolección de datos: encuesta. Instrumento: cuestionario auto administrado.
Resultados: Se comprobó
que el 52% de los enfermeros no utiliza estrategias de Resolución de problemas
por lo que no encuentran en la recreación maneras de proteger la salud mental.
El 52% no utiliza estrategias de Referencia a otros o no socializan sus
problemas y el 81% no utiliza estrategias de Afrontamiento no productivo.
Conclusión: En conclusión, el 52% del personal de
enfermería mantiene la estabilidad mental en general, y el 81% no recurre a
estrategias de afrontamiento no productivo, por lo que no manifiestan conductas
autodestructivas. El contexto de Covid- 19 tuvo efecto negativo en el 48% del
personal de enfermería.
Palabras claves: Estrategias
de afrontamiento; Salud mental; Covid -19.
0183 IMPLEMENTACIÓN DE CHECK
LIST DIARIO COMO MEJORA DE LA SEGURIDAD DEL PACIENTE EN UNA UCIP
C Berrondo(1), E
Monteverde(1), M Garea(1), P Neira(1)
(1) De Niños R. Gutiérrez.
Introducción: Los checklists son listados de acciones para
utilizarse en distintas situaciones y garantizar no saltear pasos claves. Los
listados de verificación (LV) o checklists se basan en ingeniería de factores
humanos y tienen un rol central en la seguridad del paciente.
Se han utilizado exitosamente en diferentes
áreas de la medicina: reducción de mortalidad y complicaciones asociadas a las
cirugías, con la utilización del checklist quirúrgico; mejora de la
comunicación del equipo de salud; disminución de infecciones asociadas al
cuidado de la salud (IACS); mejora de los cuidados postoperatorios,
prescripción segura de medicación, mejora del traspaso de información de
pacientes, entre otras.
En nuestra unidad de cuidados intensivos
pediátricos (UCIP) se decidió realizar la implementación de una LV al pie de la
cama para no olvidar los aspectos a evaluar en cada paciente ni las condiciones
de su seguridad.
Objetivo: Describir la implementación y desarrollo de
una LV en una UCIP polivalente.
Métodos: Desde enero de 2021 se implementó una LV de
aplicación diaria durante la recorrida de sala matinal. Se implementó en el
software KoBo Toolbox, que permite guardar los datos en el dispositivo móvil y
enviarlos con posterioridad. La LV incluyó 31 ítems en 9 categorías (tabla):
respiratorio (n=10), analgesia y sedación (n=4), nutricional (n=3), hemodinamia
(n=3), piel y mucosas (n=3), dispositivos (n=2), neurológico (n=2),
hidroelectrolítico (n=2) e infectológico (n=2).
Resultados: Entre el 1º de enero de 2021 y el 31 de julio
de 2022 se registró la realización de 3289 listas de verificación y 6470
días-paciente (tasa 50.8%). El promedio de los primeros 11 meses fue 33% y el
de los segundos 8 meses, 87.1% (gráfico). Las estrategias para mejorar la adherencia
fueron mantener una comunicación activa con los referentes de los sectores,
comunicar los hallazgos en forma regular (ateneos de servicio, información de
resultados semanal a todo el equipo). El grado de completitud fue:
hidroelectrolítico (99.1%), infectológico (98.8%), neurológico (98.2%),
nutricional (98.1%), dispositivos (97.4%), piel y mucosas (96.1%), hemodinamia
(93.9%), analgesia (90.0%) y respiratorio (64.2%).
Conclusión: La implementación de una LV en una UCIP
polivalente del sistema público es factible siendo una herramienta valiosa para
mejorar la seguridad del paciente.
G Cruz(1), C Caceres(1),
M Balceda(1), M Lamas(1), V Gallardo(1), C Tintolay(1), D Sajama(1), P
Balceda(1), N Palacios(1), G Rodriguez(1), D Crespo(1), P Baez(1), O Lopez(1),
V Limon(1)
(1) Pablo Soria.
Introducción: Durante la internación del paciente crítico,
se pudo observar que el inicio de la nutrición enteral (NE) determina el estado
de desnutrición, repercutiendo en la morbimortalidad y días de hospitalización
del mismo. Por ello es importante valorar los factores que influyen en el
inicio de la NE en este paciente.
Objetivo: Identificar los factores que influyen en el
inicio de la NE durante el período abril- junio 2022, en la UTI-HPS. Analizar,
clasificar, predecir y describir los factores y las complicaciones que surgen a
partir de la postergación del inicio de la NE.
Materiales y método: Se realizo un estudio estadístico mixto,
transversal y prospectivo, en el Hospital Pablo Soria de la ciudad de San
Salvador de Jujuy, Argentina. La población estuvo constituida por pacientes
hospitalizados desde abril a junio de 2022. La muestra está conformada por
pacientes críticos que Ingresaron al servicio de UTI durante el periodo de
abril a junio de 2022. Las variables de estudio fueron edad, sexo, días de
internación, inicio de la NE, motivos por los que no inicia la NE.
Resultados: En el periodo de tres meses ingresaron en
total 62 pacientes, 24 (39%) son < 30 años, 16 (%) tienen entre 31 a 50 años
y 22 (35%) son > 51 años. Del total 25 (40%) son mujeres y 37 (70%) son
varones. 12 (20%) iniciaron la NE en tiempo optimo, 14 (24%) iniciaron en un
tiempo temprano y 33 (56%) inicia tardíamente. Motivos por los que no inicia
NE: 3 (8%) no está indicado, 10 (26%) por patologías digestivas y 26 (67%) por
HD inestable.
Conclusión: El estudio ha servido para conocer las características
de nuestra población de referencia, como así también afirmar que el inicio de
la NE se va a ver reflejado en la estadía, evolución y mejoría del paciente
critico en nuestra UCI , por tanto, afirmamos que cuanto más temprano se inicie
la NE mayores serán los beneficios para el paciente crítico.

M Helmfelt(1), M
Picullo(1), J Maniello(1)
(1) Orlando Alassia.
Introducción: Nos situamos
en una UCI pediátrica polivalente de 12 camas, donde, se ha incorporado
recientemente el manejo postquirúrgico de Cirugia Cardiovascular. El Fallo
Renal y por consiguiente, las terapias de Reemplazo renal son una de las
principales estrategias que disponemos en UCIP para el tratamiento de los
pacientes críticamente enfermos. Históricamente la inestabilidad hemodinámica y
el tamaño de los pacientes ha sido una limitante para las técnicas de
depuración extra renal. El advenimiento de TRRC ha permitido tratar esta
población, se ha gestionado la incorporación al servicio de 2 equipos de TRRC :
Carpediem para pacientes de 2,5 a 10 kg y Amplya para pacientes mayores de 15
kg. Asimismo se incorporó un protocolo de ingreso a TRRC así como un equipo
interdisciplinario para el manejo continuo , conformado por Médicos
intensivistas del staff, Nefrólogos, Consultores, y técnicos de diálisis.
Durante el período de agosto de 2021 a julio de 2022 se realizaron 7
procedimientos en 6 pacientes, con iguales cantidades de Femeninos y
masculinos, la edad de los pacientes fue de 2 meses a 14 años. Todos los
pacientes presentaban Fallo renal, disturbios metabólicos, acidosis metabólica
e inestabilidad hemodinámica moderada a intensa. Los diagnósticos principales
fueron: shock séptico 5 pacientes. SUH 2 pacientes. Cardiopatía congénita
descompensada 1 paciente La metodología utilizada principalmente fue HDVVC Se
describen las características de los pacientes , la evolución de parámetros de
medio interno y hemodinámicos, así como los resultados mas relevantes de
morbimortalidad en UTI.
0186 LOXOSCELISMO SISTEMICO:
REPORTE DE UN CASO CLINICO
N Carbajal(1), P
Carrasco(1), P Schoon(1), L Benito(1), N Montaño(1), M Baron(1), P Anave(1), D
Suster(1)
(1) Higa Guemes Haedo.
La mortalidad por picaduras de animales
ponzoñosos tiene una letalidad del 15%. El 85% de los casos se reportan en
domicilio, las picaduras por Loxosceles Laeta representan un 4% y ocupan el
segundo lugar entre los producidos por picaduras de arañas. Solo el 10% de
estos casos evolucionan hacia una forma severa con compromiso sistémico y un
desenlace fatal.
Objetivo: Presentación del caso y revisión de la
literatura.
Presentación del caso: Paciente de 46 años, ingresa por dolor en
cara interna de muslo derecho, asociado a lesión eritematosa indurada más
flictenas, astenia, adinamia, hiporexia de 48 hs de evolución, cuadro posterior
a sensación de picadura de insecto no confirmado en domicilio 24 hs antes de
inicio de síntomas con progresión rápida de las lesiones. Al examen físico
somnolienta, muslo derecho tumefacto con dos flictenas de 2 cm sobre placa
violácea que ocupa 2/3 de muslo en su cara interna, oligoanuria.
Por sospecha de loxoscelismo sistémico vs
infección de piel y partes blandas, se administra suero anti veneno, e inicia
tratamiento antibiótico empírico.
Ingresa a UTI somnolienta, empeoramiento de
la lesión asociado a disfunciones orgánicas, se realiza toilette quirúrgica.
Evoluciona con inestabilidad hemodinamica, se amplia esquema antibiótico,
inicia hemodialisis.
Evolución favorable, mejoría de fallas
orgánicas, buena evolución de la lesión. Pasa a sala general y posteriormente
es dada de alta.
Discusión - Conclusión: La identificación del agente causal en patologías causadas por
picaduras de arácnidos es necesaria para brindar un tratamiento oportuno. El
loxoscelismo es una enfermedad de difícil diagnostico, más aun si no se
identifica al agente causal.
En la forma viscero-cutanea, la gran
similitud que comparte con un cuadro séptico de piel y partes blandas puede
llegar a confundir el diagnostico. Por lo tanto, la evaluación primaria el
diagnostico debe estar basado en un profundo y sistemático uso de la anamnesis
y de los datos epidemiológicos que se puedan recabar del paciente o el
entorno,asi sumar datos suficientes que aporten en el diagnóstico la
posibilidad de loxoscelismo sistémico en pacientes con patologías cutáneas
asociadas a disfunciones sistémicas.


R Talma(1), T
Robetto(1)
(1) Higa Dr Alende.
Como refieren Romero-Maza et.al. (2011),
determinar las cargas de trabajo, calcular el personal y la asignación de
pacientes constituye una herramienta imprescindible para la gestión del
cuidado. El TISS-28 es un método para medir la intensidad del tratamiento
cuantificado de las intervenciones que sirven para vigilar la carga de trabajo
y establecer una adecuada asignación enfermera-paciente.
Se plantea así como objetivo conocer el
esfuerzo terapéutico en el servicio de Cuidados Coronarios requerido por el
personal de Enfermería, mediante un estudio cuali-cuantitativo, descriptivo y
transversal. Muestreo no probabilístico, integrado por todos los pacientes que
se encuentren internados en el servicio de cuidados coronarios durante los
meses mayo a julio 2022; y todo el personal asistencial de enfermería vinculado
al servicio en igual período de tiempo. Se utilizó la escala Tiss 28 y encuesta
autoadministrada para enfermería como instrumento de recolección de datos.
Se lograron recolectar datos durante 25 días
con un total de 226 muestras Tiss 28, observándose una media de esfuerzo
terapéutico de 15, 9 puntos, correspondiendo a un grado II de complejidad del
paciente. Esto requiere una relación de 1 enfermera cada 4 pacientes.
El valor máximo de esfuerzo terapéutico fue
de 39 puntos, y el mínimo de 8 (anexo I).
Como resultados del análisis sociodemográfico
de un total de 19 enfermeros, todos son de sexo femenino, exceptuando uno. En
cuanto al Grado alcanzado, más de la mitad del personal es Técnico Enfermero
(63%), existiendo 1 solo Licenciado en Enfermería, sin contar con personal con
título de posgrado.
Se midió la antigüedad en el servicio, donde
se evidencia que casi la mitad del personal (47%) lleva menos de 1 año (anexo
II), lo que refleja una alta necesidad en capacitación.
Se puede observar una distribución casi
igualitaria de 6 a 4 enfermeros por turno, alcanzando la correspondiente
relación enfermera/paciente según grado de complejidad arrojado (promedio 9
pacientes internados/dia).
El porcentaje de ocupación de camas en el
servicio fue del 75%, ajustándose a las normas de organización y funcionamiento
de los servicios de cuidados intensivos.
Por último, podemos afirmar que la presencia
de un paciente sometido a cirugía cardiovascular aumenta la carga de Tiss 28.


0188 FALLA MULTIORGÁNICA DEBIDA
A MORDEDURAS MÚLTIPLES DE ARACNIDOS
S Ruiz Laos(1), J
Morales Corvacho(2)
(1) Regional. (2) Clinica Montefiori.
Introducción: Las mordeduras de arañas son eventos
frecuentes y usualmente no graves, pero pueden revestir mucha gravedad,
requerir medidas de soporte vital extraordinario y comprometer la vida.
Caso clínico: Se presenta el caso de un varón, de 34 años,
agricultor, previamente sano, que presenta en pocas horas grave compromiso
multisistémico, debido, probablemente a mordedura múltiple de arácnidos,
ocurrido en una estancia, al quedarse dormido en un ambiente poco higiénico,
después de haber ingerido licor. Se le encontró confuso, hipotenso, con
múltiples lesiones en manos, pies, tórax, abdomen y cara, sugestivas de
mordedura de arácnidos, y que presenta a su ingreso a Emergencia, cuadro
convulsivo refractario, dificultad respiratoria, hipotensión arterial,
disfunción renal y alteraciones hematológicas, de instalación rápida, por lo
que fue admitido a Terapia intensiva y requirió medidas de soporte vital
extraordinario. Su evolución fue favorable en UCI saliendo de alta al séptimo
día.
Discusión: Se presenta el caso, por ser una complicación
rara por su gravedad y compromiso multisistémico causado, aparentemente, por
mordeduras múltiples de arácnidos. Es probable que, por haberse producido en un
ambiente cerrado y de campo estén involucradas varias especies de arácnidos,
principalmente Latrodectus y Loxoceles; El hecho de que el paciente haya
ingerido licor también puede haber influido en los reflejos de defensa. La
gravedad del cuadro producido por toxinas está en relación directa con la
magnitud del inóculo y la susceptibilidad del paciente, por lo que las
múltiples mordeduras, nos hace suponer una magnitud de inóculo muy grande, lo
que explicaría la severidad del cuadro. Las especies de Latrodectus producen
neurotoxinas y las Loxoceles toxinas con importantes efectos locales, que
pueden llegar a la necrosis dérmica, hemolisis, daño renal e incluso necrosis
visceral. Por la magnitud y diversidad de los sistemas comprometidos, es
probable la participación de más de una especia de arácnido. El manejo se
centró en medidas de soporte vital, medicación anticonvulsivante, corticoides y
antibióticos.
Conclusión: Las mordeduras múltiples de arácnidos pueden
desencadenar cuadros tan graves como una falla multiorgánica que ponga en
peligro la vida.


S Bernthal, J
Bartoli(1), M Guereschi(1), F álvarez(1), M Heredia(1), A Muhlberger(1), J
Múrtula Ferreyra(1), G Martini(1)
(1) Clínica Universitaria Reina Fabiola.
Introducción: Bevacizumab
es un anticuerpo monoclonal recombinante que se dirige al factor de crecimiento
endotelial vascular, un mediador de la angiogénesis y la permeabilidad
vascular. Ha demostrado actividad antitumoral cuando se combina con varios
agentes quimioterapéuticos citotóxicos y se han realizado ensayos para evaluar
la eficacia en diferentes tumores. Los eventos adversos descritos son
numerosos, siendo la hemorragia grave uno de ellos.
Presentación del caso: Paciente masculino de 82 años, con
antecedentes de tumor fibroso solitario de pleura recidivante, con
requerimiento de tres intervenciones quirúrgicas y quimioterapia con
temozolomida, bevacizumab y pazopanib, por progresión de la enfermedad. Cursa
internación por Neumonía adquirida de la comunidad. Intercurre con shock
hemorrágico y requerimiento de transfusión de hemoderivados. Por
angiotomografía se diagnostica hematoma retroperitoneal izquierdo infrarrenal
con signos de sangrado activo de arterias lumbares izquierdas L2 y L3 con
requerimiento de embolización y colocación de 5 coils por hemodinamia. Falleció
posterior a estadía prolongada en UTI.
Discusión: El presente reporte de caso, plantea la
hipótesis de que la aparición de hematoma retroperitoneal espontáneo podría
estar asociado con el tratamiento con bevacizumab. Es un evento raro, pero
descripto en la bibliografía. Según estudios farmacocinéticos, la vida media de
bevacizumab es de hasta 50 días. El paciente recibió además tratamiento con
pazopanib, otro antiangiogénico inhibidor de la tirosina cinasa de los
receptores del factor de crecimiento endotelial vascular, del que se
describieron también eventos hemorrágicos.
El efecto tóxico más frecuente a corto plazo
es la mielosupresión. No existen estudios en los que se analicen eventos
adversos posteriores al tiempo de vida media del fármaco.
Conclusión: A partir del presente caso, destacamos la
necesidad de sospechar que la hemorragia retroperitoneal espontánea severa
podría ser consecuencia del tratamiento antiangiogénico, independientemente del
tiempo de exposición a inhibidores del receptor del factor de crecimiento
endotelial vascular.


S Gigena(1), MG
Covello(1), EM Noli(1), M Bezzi(1), S Borello(1), R Mattei(1), G Jove(1), D
Masuello(1), ML Laurens(1), M Mastandrea(1), G Rodriguez D´aversa(1), N
Suarez(1), F Rodriguez(1), F Gonzalez Piña(1)
(1) Santojanni.
Introducción: Durante la fase de soporte parcial de la
ventilación mecánica invasiva (VMI), la actividad muscular excesiva podría
favorecer la lesión pulmonar auto infligida por el paciente por lo que sería
beneficioso evitar valores excesivos de presión plateau (PP) y driving
pressure. La manometría esofágica es el patrón de oro para identificar el nivel
de esfuerzo muscular, aunque es poco utilizado. Dicha técnica podría compararse
con maniobras no invasivas más sencillas de utilizar, como la presión de
oclusión en los primeros 100 milisegundos (P0.1) y la presión de oclusión
(Pocc). Sin embargo, actualmente no se ha evaluado su confiabilidad.
Objetivos: Determinar la confiabilidad intra e
inter-evaluador para medir el impulso respiratorio, el esfuerzo muscular y la
mecánica respiratoria a través de P0.1, Pocc y PP. Por otro lado, analizar la
correlación entre P0.1 y Pocc.
Materiales y Método: El estudio se realizó en la Unidad de
cuidados intensivos del Hospital Donación Francisco Santojanni, entre marzo y
junio de 2021. Se realizó un análisis de concordancia mediante el método de
correlación intraclase, la viabilidad de la evaluación y la correlación entre
la P0.1 y Pocc. Las mediciones fueron realizadas por un evaluador experto (EE)
y otro inexperto (EI).
Resultados: Se realizaron
49 mediciones en 19 sujetos. La media de edad fue de 55 años (14,2) y de los
días de VMI 19 (8). Se identificó una correlación intra-evaluador excelente
(EE) y buena (EI) para P0.1, y excelente para Pocc y PP de ambos evaluadores.
La confiabilidad inter-evaluador fue excelente para P0.1 y Pocc, y buena para
PP. La presencia de esfuerzo espiratorio al momento de la medición de PP se
evidenció en el 41% de las evaluaciones. La P0.1 y la Pocc se correlacionaron
de forma moderada (0,69). (Ver tablas 1 y 2)
Conclusión: Los valores de confiabilidad intra e
inter-evaluador fueron buenos a excelentes en las maniobras no invasivas
durante la fase de soporte parcial. La P0.1 y la Pocc se correlacionaron de
forma moderada.


R Mattei(1), G
Covello(1), S Gigena(1), EM Noli(1), M Bezzi(1), S Borello(1), G Jove(1), D
Masuello(1), ML Laurens(1), M Mastandrea(1), G Rodriguez D´aversa(1), N
Suarez(1), F Rodriguez(1), L Silvani(1)
(1) Santojanni.
Introducción: Durante la pandemia del SARS-CoV-2, un alto
porcentaje de sujetos desarrollaron neumonía por COVID-19. En varios países,
hubo dos olas y se informó que la tasa de mortalidad fue más baja durante la
segunda. En Argentina se han descripto características epidemiológicas y
ventilatorias de los sujetos que requirieron cuidados críticos durante la
primera ola, sin embargo, se desconocen datos que hagan una comparación con la
segunda.
Objetivo: Describir las características clínicas,
parámetros ventilatorios y de mecánica respiratoria con variables de desenlace,
comparando a los sujetos de ambas olas.
Materiales y método: Estudio observacional, descriptivo y
prospectivo. Se incluyeron a los sujetos de dos Unidades de Cuidados Intensivos
del Hospital Donación Francisco Santojanni, con diagnóstico de neumonía por
COVID-19, que requirieron ventilación mecánica invasiva (VMI) por al menos 24
horas. Se consideró primera ola desde abril hasta septiembre de 2020 y segunda
ola desde abril hasta agosto de 2021. El análisis estadístico se realizó
mediante la prueba de χ2, t de Student o U de Mann-Whitney. Se
estableció un valor de p≤0,05 como estadísticamente significativo.
Resultados: Se incluyeron 81 sujetos en la primera ola y
112 en la segunda. Los puntajes de severidad de ingreso fueron
significativamente mayores en la primera ola: SAPS II (58 (40-67) vs. 49
(26-60); p=0,002), APACHE II (23 (17-27) vs. 20 (15-24); p=0,040) y SOFA (8
(6-11) vs. 7 (3-8); p=0,001). Durante la segunda ola, en los días 1, 3 y 7 de
VMI, se encontraron mayores valores de PEEP y presión meseta y al día 1 la
compliance fue menor y el poder mecánico mayor, con significancia estadística.
La utilización del decúbito prono fue significativamente menor en la primera
ola (41 (50,6) vs. 79 (70,5); p=0,000) y la mortalidad significativamente mayor
(62 (76,5) vs. 75 (67); p=0,020) (ver tablas 1 y 2).
Conclusión: En las dos olas se observaron parámetros
ventilatorios dentro de los valores protectores. Durante la segunda ola la
mortalidad disminuyó, los sujetos eran más jóvenes y presentaban menor gravedad
al ingreso.


N Fermin(1)
(1) Sanatorio Anchorena.
Introducción: El Síndrome de Obstrucción sinusoidal es una
complicación asociada con el trasplante de medúla osea .La incidencia media es del
13,7 % en general, presentado disfunción multiorganica en un tercio de los
pacientes con una tasa de mortalidad > 80%, el diagnostico se basa en
criterios clínicos.
Presentación del caso: Se describe el caso de un paciente masculino
de 19 años de edad con, diagnóstico de Leucemia Linfoblástica Aguda B en
febrero de 2019 refractaria en cuarta línea de tratamiento con Inotuzumab-
ozogamicin por un ciclo con posterior EMR 0.02, se consilida con TPH.
Ingresa a Internación General en febrero de
2021 en plan de trasplante haploidentico de donante geneticamente relacionado,
realiza régimen condicionante con TBI Y Etoposido presentado en las primeras 24
horas Neutropenia febril , aumento de peso de 5 kilogramos en 72 horas sin
respuesta a diurético , ascenso de valor de bilirrubina a triple de valor de
ingreso 1.12 mg/dl . Evolucionando con falla hepática BT:23 mg/dl asociado a
progresión exponencial de falla renal , respiratoria , hemodinámica que
requiere terapia de soporte . Ante factores de riesgo a quimioterapia y
trasplante se sospecha de Sindrome de Obstrucción Sinusoidal con limitación de
confirmación diagnóstica por plaquetopenia severa y falta tratamiento
especifico , falleciendo en marzo 2021.
Discusión: Tradicionalmente el diagnóstico se ha basado
en los criterios de Baltimore sin embargo el curso y la entre adolescentes y
adultos jóvenes pueden ser difíciles de predecir por lo que se propuso nuevas
pautas de diagnóstico (Tabla 2).
Varios análisis han mostrado una asociación
entre el diagnóstico utilizando los criterios de Seattle modificados y mejores
resultados versus resultados en pacientes diagnosticados con los criterios de
Baltimore más estrictos , demostrando que la intervención temprana se asocia
con una mejor supervivencia general. En consecuencia, se ha puesto un énfasis
renovado en un diagnóstico basado en la sospecha clínica relacionada a factores
de riesgo .
Conclusión: Esta patología se presenta en población
pediátrica con criterios diagnósticos mas sutiles , con rápida progresión ; por
lo tanto es importante la alta sospecha clínica para inicio de tratamiento
temprano .


J Caridi(1), L
Viterbo(1), E Monteverde(1), P Neira(1)
(1) Hospital De Niños Dr. Ricardo Gutiérrez.
Introducción: Las infecciones respiratorias agudas bajas
(IRAB) representan una importante causa de morbimortalidad alrededor del mundo.
En Argentina los menores de 2 años constituyen el grupo etario más vulnerable y
con mayor mortalidad.
Objetivo: Describir la evolución de la mortalidad en la
unidad de cuidados intensivos pediátricos (UCIP) en los menores de 2 años con
IRAB. Adicionalmente, describir las características clínicas de los pacientes e
identificar factores asociados a los cambios en la tendencia de mortalidad.
Métodos: Se realizó un estudio observacional,
retrospectivo y longitudinal en la UCIP de un hospital pediátrico de
referencia. En este reporte parcial se incluyeron aquellos pacientes que
ingresaron con diagnóstico de IRAB durante el período de abril de 2017 a
diciembre del 2020.
Resultados: Se analizó una muestra de 185 pacientes
obteniéndose un total de 4 fallecidos (2.2%) y una tasa de mortalidad
estandarizada (TME) de 0.435 (IC 95% 0.134-0.778). En 2017-2019 se encontró una
letalidad por debajo de la esperada. Para 2017: 0.0 (IC 0-0.769), para 2018:
0.4 (IC 0.01-0.953) y para 2019: 0.6 (IC 0.084-0.978). Durante 2020 se observó
un incremento en la letalidad: 7.1% vs. 1.8% (promedio 2017-2019) y en la TME:
1.17 (IC no calculable).
La mediana de edad fue de 7 meses (rango
intercuartil 4-12) y el 59.5% tuvo al menos una condición crónica compleja. Las
más prevalentes fueron: respiratorias, cardiovasculares y congénitas o
genéticas. En el 72.4% de los casos se aisló un germen de las secreciones
respiratorias; el virus sincicial respiratorio constituyó casi un 30%, seguido
por Metapneumovirus, Parainfluenza y Adenovirus. Un 82% de los pacientes
requirió asistencia respiratoria mecánica (mediana de 9 días). La prevalencia
de complicaciones asociadas a los cuidados de la salud fue 41.2%.
Conclusiones: Los incrementos observados en 2020 en la letalidad
y la TME posiblemente se asocien con factores relacionados con los pacientes
(tabla 1) y con factores externos relacionados con la pandemia de COVID-19
(menor cantidad de pacientes, cambios en la circulación habitual de patógenos,
consulta tardía y alteración de los procesos asistenciales).


C Gonzalez(1), G
Musso(1), JR Louzan(1), G Appendino(1), C Gomez(2), D Latasa(1), A Lopipi(1), J
Rango(1), S Calabrono(1), G Sterzer(1), L Finos(1), M Cavagnari(1), G
Suarez(1), G Alessio(1), L Berloni(1), E Pizzo(1), A Abarca(1), L Clemente(1),
M Manago(1), C Lovesio(1), E Estenssoro(3)
(1) Sanatorio Parque. (2) Sanatorio Parque”.
(3) Hospital Intrzonal De Agudos San Martin De La Plata.
Introducción: La identificación temprana de los pacientes
con falta de respuesta a la posición prona permite otros tratamientos que
podrían disminuir la mortalidad. El objetivo de nuestro estudio fue: describir
las características, comportamiento de la oxigenación y mecánica pulmonar en
pacientes con SDRA con ventilación mecánica por SARS-CoV-2 tratados con
posición prona. Los objetivos secundarios fueron identificar determinantes
independientes de la mortalidad; en particular, el número de ciclos asociados
con mayor mortalidad.
Métodos: Fue un estudio prospectivo. Todos los
pacientes con paO2/FiO2 < 150mmHg fueron incluidos y se clasificaron según
el comportamiento de la paO2/FiO 2. También se registró el número de ciclos
pronos. Las características basales, las scores de gravedad, mecánica
respiratoria y el comportamiento de la relación PaO 2/FiO2 se compararon entre
sobrevivientes y no sobrevivientes.
El análisis estadístico se realizó mediante
las pruebas de Mann Whitney, Chi² Test y Wilcoxon range test. Los factores
independientes asociados con la mortalidad hospitalaria se identificaron
mediante regresión de Cox.
Resultados: 273 fueron tratados con posición prona
durante 18 meses. La PaO2/FiO2 basal fue de 116 [97-135] mmHg (115 [94-136] en
supervivientes versus 117 [98-134] en no supervivientes; p=0,50). Después de la
posición prona, 22 pacientes (8%) tuvieron el mismo valor en la relación
PaO2/FiO2; 46 pacientes (16%) mostraron un aumento igual o igual al 25%; en 55
pacientes (21%) hubo un aumento entre el 25 y el 50% sobre el valor basal; y en
150 pacientes (55%) el aumento fue superior al 50%. La mortalidad fue del 86%,
87%, 72%, 50% respectivamente. (pág<0.001). Haber debutado con PaO2/FiO2
< 100 mmHg no implicó que el paciente fuera refractario a la posición prona.
De los 273 pacientes, 127 (46%) requirieron 1
ciclo prono, 57 (20%) 2 ciclos, 50 (17%) 3 ciclos, 17 (6%) tuvieron 4 ciclos y
19 (7%) 5 o más ciclos. La mortalidad fue de 55%, 70%, 70%, 82% y 70%
respectivamente (p<0,001). Los factores asociados independientemente con la
mortalidad fueron el porcentaje de aumento de PaO2 / FiO2 después de 24 horas
en prono, edad y el número de ciclos propensos.
Conclusiones: Después de las primeras 24 horas en la
posición prona, el porcentaje de aumento de PaO2 / FiO2 sobre el valor basal,
más allá de su valor inicial, se asoció de forma independiente con una mayor
mortalidad.
Los pacientes mayores, que no pudieron
mejorar la PaO2/FiO2 después de 24 horas en prono y que requieren más de 1
ciclo propenso, pueden ser candidatos para otros tratamientos para la hipoxemia
refractaria.
0199 CAMBIOS PRE Y POST
PANDEMIA EN LA UTI DEL HOSPITAL COMUNITARIO DE PINAMAR
C Mendoza Hadad(1),
VH Rogers(1), M Aquino(1), MR Ayala(1), L Bobone(1), A Colombani(1), D
Curuchet(1), JA Chuquipoma Diaz(1), E Deza Chingel(1), GP Formica(1), A
Gabrieloni(1), ME Garcia(1), ME Gonzalez(1), L Guzmán Cerezo(1), V Mandich(1),
M Melia(1), G Perez(1), M Porco(1), J Pui(1), YM Pui(1), J Rodriguez
(1) Hospital Comunitario De Pinamar.
Introducción: En la literatura no existe evidencia al
respecto de los cambios demográficos provocados en las Unidades de Terapia
Intensiva (UTI) secundarios a aumentos poblacionales intra y post pandemia
registrados en centros urbanos del interior del país, como el caso de la ciudad
de Pinamar en la Provincia de Buenos Aires.
Objetivos: Comparar aspectos demográficos pre y post
pandemia en la UTI del Hospital de Pinamar
Materiales y método: Estudio observacional de cohorte
retrospectivo en adultos, en una UTI polivalente. Las variables se expresaron
como media, desviación estándar, mediana, rango intercuartílico, frecuencia
absoluta y porcentaje. La comparación se realizó mediante Chi-Cuadrado, prueba
de Fisher, Test de la mediana y t de Student según correspondiera. Nivel de
significancia: p <0.05.
Resultados: Reclutados 96 pacientes durante el primer
semestre del año 2019, y 105 en el primer semestre de 2022, no se observaron
diferencias significativas en: número de pacientes, aunque se incremento un
9,4% en el 2° periodo, edad (61 vs 59 [IC 95%: 2(-3.08;7.19)]; p= 0,43), sexo
masculino (74% vs 63.8%; p: 0,12), días de internación (3 [IC 95%: 0 (0; -1)];
p= 0,46), requerimientos de ventilación mecánica (43% vs 39%; p=20), mortalidad
(30% vs 29%; p= 0,54), uso de antibióticos (36% vs 42% p= 0,71), diagnósticos
(p=0,59), derivaciones (19% vs 23%; p=0,49). Se han encontrado diferencias
estadisticamente significativas en la aparición de complicaciones (18% vs 7%,
p< 0,05) y en los procedimientos quirúrgicos (2% vs9%, p=0,02).
Conclusiones: Durante el primer semestre del 2022 se
evidenció un aumento del 9,4% en los pacientes ingresados en la UTI del
Hospital Comunitario de Pinamar, en coincidencia con un aumento poblacional de
aproximadamente el 20%, según datos estimados por la municipalidad de dicha
ciudad . Aunque este aumento no es significativo estadísticamente por el
momento, marca una tendencia que merece ser atendida. Por otro lado, se
mantienen las características demográficas de los pacientes; siendo destacable
el mantenimiento del uso y tipo de antibióticos, la disminución de las
complicaciones registradas y el aumento de prácticas quirúrgicas.


0200 Meningitis tuberculosa en
paciente con etilismo crónico
MN Göldy(1), A
Bianchi(1), J Gironacci(1), N Ortiz(1), E Gonzalez(1), R Martinez Oveid(1), G
Izaguirre(1), L Talamonti(1), S Sanchez(1), G Elías(1)
(1) Hospital Provincial De Rosario.
Introducción: La meningitis tuberculosa representa el 1%
anual de todos los casos de Tuberculosis y es la forma de presentación más
letal, con una mortalidad de hasta el 30%.
Presentación del caso: Varón de 56 años, etilista (6 litros de
cerveza por día) ingresa por cuadro de 5 días de desorientación, fiebre,
cefalea y conducta agresiva. Laboratorio: anemia, hiponatremia, reactantes de
fase aguda elevados, HIV negativo.
TAC de cráneo normal. RX tórax sin
particularidades. LCR: pleocitosis leve, hiperproteinorraquia e
hipoglucorraquia, directo y cultivo para gérmenes comunes negativos, Filmarray
negativo. Comienza con antibióticos y antivirales empíricamente y por falta de
respuesta, con progresión de foco neurológico, se agregan
antituberculostáticos. Se realiza 2º PL con PCR positiva para TBC.
Luego de 72 horas de tratamiento, mejoró su
estado general y neurológico, con posterior alta hospitalaria continuando con
antibacilares ambulatoriamente.
Discusión: Debido al cuadro clínico mencionado se
sospecha meningoencefalitis aguda.
La realización de TAC de cráneo y punción
lumbar diagnóstica es mandatoria.
Se obtiene un LCR con pleocitosis leve,
hipoglucorraquia e hiperproteinorraquia con filmarray negativo y directo y
cultivo para gérmenes comunes negativos.
Debido a la progresión del cuadro neurológico
se interpreta como falta de respuesta al tratamiento inicial, por lo cual se
realiza nueva punción lumbar con PCR positiva para TBC.
La evolución clínica sin respuesta al
tratamiento, sumado a la inmunosupresión y las características del LCR obliga
la sospecha de TBC meníngea con el consiguiente tratamiento empírico y la
realización de métodos diagnósticos para su confirmación.
Conclusión: La TBC meníngea es una entidad clínica
infrecuente con alta mortalidad debido al retraso en el diagnóstico,
recomendándose el tratamiento empírico precoz. Se debe tener una alta sospecha
en cuadros que no responden al tratamiento y en especial en inmunodeprimidos.
Sin embargo se está registrando un aumento en la incidencia de tuberculosis
meníngea en los últimos años incluso en personas inmunocompetentes.
0202 Miocardiopatía séptica:
utilidad diagnóstica del strain longitudinal global
F Daldoss(1), A
Sosa(1), A Matarrese(1), BA Lucía(1), Y Giuliano(1)
(1) Hospital Alemán.
Introducción: La miocardiopatía séptica (MS) es una entidad
frecuente aunque su incidencia e implicancia pronóstica no están completamente
definidas.
Dado que no existen criterios diagnósticos
unificados de MS, diferentes parámetros ecocardiográficos se han utilizado para
su definición tales como la fracción de eyección (FEY) y el strain longitudinal
global (SLG).
Múltiples estudios han explorado la
asociación entre el SLG del ventrículo izquierdo (VI) y mortalidad en pacientes
sépticos, aunque sus resultados aún no son concluyentes.
Proponemos establecer la prevalencia de MS
según diferentes mediciones ecocardiográficas y su asociación con mortalidad en
pacientes internados en UCI por sepsis o shock séptico.
Materiales y métodos: Se analizó en una cohorte prospectiva de 52
pacientes admitidos a la UCI con diagnóstico de Sepsis según definición de
Sepsis 3 desde el 1 de noviembre de 2021 hasta el 31 de mayo de 2022. Durante
las primeras 24 horas se evaluó disfunción VI según FEY, excursión sistólica
del anillo mitral (MAPSE), SLG VI calculado según MAPSE y longitud del VI
(STRAIN-VI) y SLG por speckle-tracking (SLG-VI). Se analizaron variables como
edad, sexo, APACHE II, SOFA, días de internación y mortalidad en unidad de
cuidados críticos (UCI).
Resultados: Se analizaron 52 pacientes. Mortalidad global
34.6% (n = 18). La prevalencia de miocardiopatía séptica varió según el método
utilizado entre 39% (FEY) y 96% (SLG.VI).
Al evaluar la asociación entre la
miocardiopatía séptica definida por diferentes métodos y la mortalidad en UCI
cruda, la medición asociada significativamente fue MAPSE promedio (OR = 3.66,
95%CI: 1.01 - 13.5; P=0.046). Realizando el modelo multivariado ajustado por
edad y sitio de infección la variable asociada significativamente con mortalidad
fue STRAIN-VI (OR = 9.01, 95%CI: 1.11 - 160.5; P=0.047).
Conclusión: La prevalencia de MS varía dependiendo del
método ecocardiográfico utilizado. Teniendo en cuenta los valores de corte
reportados en la literatura, la única medición asociada a mortalidad
independientemente de la edad y sitio de infección fue STRAIN-VI. Se necesitan
estudios para determinar el mejor método y valores de corte para definir
miocardiopatía séptica con el mejor desempeño diagnóstico/pronóstico.


0205 Probióticos: ¿Son
realmente inofensivos?
GL Capdevila
Vicente(1), PB Pahnke(1), MC Vignetta(1), S Paván(1), A Lopez(1), I Herrero(1),
MV Vignolo(1), I Ocampo(1), S Cabiedes(1)
(1) Hospital Municipal De Urgencias.
Introducción: Los probióticos son “microorganismos vivos no
patógenos, que, administrados en cantidades adecuadas, confieren un beneficio a
la salud”, reduciendo las infecciones. Las esporas de Bacillus clausii,
están indicadas para tratamiento y profilaxis de las alteraciones de la flora
intestinal que provocan diarrea y para recuperar el desequilibrio secundario a
tratamiento con antibióticos. Si bien los resultados son prometedores no hay
evidencias para una recomendación sólida.
Presentación del caso: Femenina, 51 años sin inmunocompromiso,
ingresa al Shock Room del HMU, Córdoba por degloving de miembro inferior
derecho TSCHERNE III secundario a colisión moto vs camión. Con 31
intervenciones quirúrgicas entre toilettes y autoinjerto de piel. Cursa
internación en UTI con antibióticos prolongados por múltiples gérmenes en
tejido del injerto. Nutrición enteral por sonda nasogástrica. Complicada con
úlceras en unión gastroesofágica, gastrostomía con intolerancia alimentaria y
finalmente yeyunostomía. Presenta diarrea crónica descartándose enteroinvasivas
y citotóxicas, y se administra B. clausii 21 días. Pasadas 48 horas del
tratamiento, hemocultivos positivos para Bacilo Gram + sin tipificación con
tratamiento empírico (piperacilina-tazobactam + amikacina + colistin), a los 12
días cultivos diferidos positivos para B. clausii. Levofloxacina +
vancomicina 21 días. Ecocardiograma transtorácico y transesofágico sin
vegetaciones. Alta hospitalaria con levofloxacina + minociclina por 6 semanas.
Hemocultivos control negativos.
Discusión: Existe escasa bibliografía sobre uso y
complicaciones por B. clausii. Se identificaron 3 casos de bacteriemia
por este germen. Halvorsen et al emitieron una advertencia contra el uso de
probióticos en pacientes con diarrea por antibióticos. Kothari et al indicaron
que la sepsis está relacionada con translocación bacteriana a través de pared
intestinal deteriorada. Las revisiones sugieren más estudios para abordar
dosis, cepas, duración, vía de administración y poblaciones para tratamiento con
probióticos.
Conclusión: Bacillus clausii es una promisoria modalidad terapéutica,
pero usarla en pacientes inmunocomprometidos y críticos es cuestionable por su
capacidad de translocar al torrente sanguíneo. Si bien la tendencia de uso es
positiva, la evidencia aún no la recomienda.

0206 SÍNDROME CORONARIO AGUDO
SECUNDARIO A ROBO CORONARIO: A PROPÓSITO DE UN CASO
N Grassi(1), CJ
Beroiza(1), M Cruz(1), LG Durán(1), VA Millán(1), MG Montenegro Fernandez(1), M
Petasny(1), NI Zelaya De León(1), P Zorzano Osinalde(1)
(1) Hospital Municipal De Agudos Leonidas
Lucero.
Introducción: Las fístulas coronarias entendidas como una
comunicación entre una de las arterias coronarias y una vena o cavidad cardíaca
constituyen la anomalía congénita coronaria más frecuente. Su localización más
habitual es en la arteria coronaria derecha (55% de los pacientes) y en la
arteria coronaria izquierda (35% de los casos).
Presentación del caso: Paciente femenina de 39 años con antecedentes
de miocardiopatía dilatada diagnosticada en la infancia, con seguimiento
errático, ambigüedad genital (realizó tratamiento quirúrgico con anexo
histerectomía y reemplazo hormonal que discontinúa por disponibilidad), que es
traída por el sistema prehospitalario en paro cardiorrespiratorio desde el
domicilio, donde constatan ritmo de fibrilación ventricular y taquicardia
ventricular, con reanimación exitosa posterior a 2 desfibrilaciones, ingresa
inestable hemodinámicamente con requerimiento de noradrenalina, se intuba y
pasa a terapia intensiva. Se realiza electrocardiograma que muestra
supradesnivel del ST en V3-V4, y ondas T negativas en V5-V6. Se realiza
cinecoronariografía que informa arteria coronaria izquierda sin obstrucciones
angiográficas, con múltiples fístulas que drenan hacia la arteria pulmonar y al
seno coronario.
Se interpreta como un síndrome coronario
agudo secundario a “robo coronario”. Se instaura tratamiento con amiodarona.
Evoluciona con mal despertar, sin contenido de conciencia, secundario a
encefalopatía hipóxica. Se realiza electroencefalograma que descarta status
epiléptico. Permanece diez días en terapia intensiva, buena evolución,
extubación exitosa. Luego de veintiséis días se otorga el alta hospitalaria.
Discusión: El cuadro clínico de la mayoría de los
pacientes es asintomático, siendo los diagnósticos hallazgos imagenológicos.
Las complicaciones más frecuentes son hipertensión arterial pulmonar junto a la
insuficiencia cardiaca congestiva, endocarditis bacteriana, rotura o trombosis
de la fístula, isquemia miocárdica distal a la fístula como consecuencia de un
“robo miocárdico”, entre otros. La presentación sintomática de este evento es
mandatorio de resolución quirúrgica o endovascular. La paciente presentaba de
base miocardiopatía dilatada, la cual probablemente enmascaró la anomalía
vascular. En vista de asociación de patologías congénitas considerar en este
tipo de pacientes la importancia en la pesquisa de comorbilidades.
Conclusión: Las fístulas pequeñas se asocian a un buen
pronóstico a largo plazo, la presentación referida en el presente caso supone
un desafío en el diagnóstico de dicha entidad.
0207 UTILIZACION DE RECURSOS
PRE Y POST PANDEMIA EN LA UTI DEL HOSPITAL COMUNITARIO DE PINAMAR
C Mendoza Hadad(1),
VH Rogers(1), M Aquino(1), MR Ayala(1), L Bobone(1), A Colombani(1), D
Curuchet(1), JA Chuquipoma Diaz(1), E Deza Chingel(1), GP Formica(1), A
Gabrieloni(1), ME Garcia(1), ME Gonzalez(1), L Guzmán Cerezo(1), V Mandich(1),
M Melia(1), G Pérez(1), M Porco(1), YM Pui(1), J Pui(1), J Rodriguez
(1) Hospital Comunitario De Pinamar.
Introducción: En la literatura no existe evidencia al
respecto de los cambios provocados en las Unidades de Terapia Intensiva (UTI)
secundarios a los aumentos poblacionales intra y post pandemia registrados en
centros urbanos del interior del país, como el caso de la ciudad de Pinamar en
la Provincia de Buenos Aires
Objetivos: Comparación pre y post pandemia de la
utilización de recursos en la UTI del Hospital Comunitario de Pinamar.
Materiales y métodos: Estudio observacional, retrospectivo. Se
incluyeron los registros de pacientes mayores de 18 años ingresados a UTI
durante el primer semestre del año 2019 y primer semestre del año 2022. Las
variables numéricas se expresaron como media, desviación estándar, mediana,
rango intercuartílico; las variables categóricas frecuencia absoluta y
porcentaje. La comparación de variables categoricas se realizó mediante
Chi-Cuadrado, prueba de Fisher, y las numéricas Test parametricos y no parametricos
según correspondiera. Nivel de significancia: p <0.05.
Resultados: Reclutados 96 pacientes durante el primer
semestre del año 2019, y 105 en el primer semestre de 2022, no se observaron
diferencias ESTADISTICAMENTE significativas en: número de pacientes, aunque se
incremento un 9,4% en el 2° periodo, diferencia de mediana de días de
internación 3 (IC95%): 0 (0-1) , utilización de catéteres de vía central (47,9%
vs 49,5% p= 0,82), ventilación mecánica (44,8% vs 38,1% p= 0,20), medición de
tensión arterial invasiva (8,3% vs 14,3% p= 0,18), inotrópicos 38,5% vs 36,2%
p= 0,73), sedoanalgesia (36,5% vs 25,7% p= 0,09), derivación de pacientes
(18,9% vs 22,9% p= 0,49) respectivamente.
Conclusiones: Durante el primer semestre del 2022 se
evidenció un aumento del 9,4% en los pacientes ingresados en la UTI del
Hospital Comunitario de Pinamar, en coincidencia con un aumento poblacional de
aproximadamente el 20%. Aunque dicho aumento no es significativo
estadisticamente marca una tendencia que merece ser evaluada en próximos
períodos. Este incremento aún no impacta en la utilización de recursos,
necesidad de derivación ni días de internación. Merece una consideración
especial, la utilización de cánula nasal de alto flujo, la cual no pudo ser
correctamente evaluada dado que fue un recurso no disponible en 2019, pero
seguramente dicha práctica será cada vez más frecuente, impactando en los días
de internación y utilización de sedoanalgesia. Siendo la disminución de este
ultimo parámetro de significancia clínica aunque no todavía de significancia
estadística.
La detección precoz de los cambios
poblacionales y su impacto en el sistema de salud es de fundamental importancia
para la correcta gestión de recursos, fortalecimiento de sectores críticos y
generacion de redes sanitarias eficientes en la derivacion de pacientes que por
su gravedad así lo requieran.


S Magee Bahl(1), P
Neira(1), E Monteverde(1), D Turina(1)
(1) Ricardo Gutierrez.
Introducción: El accidente cerebrovascular (ACV) en
pediatría es una de las 10 principales causas de muerte. Se clasifica en
isquémico y hemorrágico. Más del 60% de los pacientes que presentan un ACV
requiere internación en la unidad de cuidados intensivos pediátricos (UCIP).
Objetivo: Describir las características de los
pacientes con diagnóstico de ACV ingresados en la UCIP del Hospital de Niños
Ricardo Gutiérrez.
Métodos: Análisis observacional, retrospectivo,
unicéntrico, con recolección de datos de la base SATI-Q. Pacientes entre 0 y 18
años, ingresados en el período 7/2017 – 8/2022. Las variables analizadas se
expresan como mediana y rango intercuartil (RIC) o cantidad y porcentaje.
Resultados: Durante el período de estudio ingresaron 27
pacientes, siendo 18 (66,7%) ACV hemorrágicos y 9 (33,3%) isquémicos. La
mediana de edad de presentación fue 9 años (RIC 5-12), 63% de sexo femenino. El
56,5% presentó al menos una condición crónica compleja (CCC), predominando la
causa congénita (30,4%), neurológica (17,4%) y hematológica (17,4%).
La TC de cerebro fue el primer estudio en
todos los pacientes y el 77,8% recibió anticonvulsivantes como primera medida
terapéutica. La estadía en la UCIP tuvo una mediana de 4 días (RIC 2,5-13) y el
77,8% requirió asistencia ventilatoria mecánica (AVM) con una mediana de 4 días
(RIC 1-8).
Fallecieron 5 pacientes (18,5%) con una tasa
de mortalidad estandarizada de 3,03 (IC no calculable).
El 40,7% de la muestra tuvo un puntaje de 5
(buena recuperación) en el Glasgow Outcome Scale (GOS) al egreso de la UCIP
seguido del 22,2% con 4 (discapacidad moderada).
Conclusión: En esta muestra analizada se observó una
mayor proporción de ACV hemorrágico y más de la mitad de los pacientes
presentaron CCC.
Si bien la mortalidad fue mayor a la
esperada, un gran porcentaje egresó de la UCIP con buena recuperación
neurológica.
El ACV en pediatría es una entidad de baja
incidencia pero su reconocimiento precoz puede ayudar a limitar las secuelas.
AL Ramirez Ayala(1),
M Gilli(1)
(1) Fiorito.
Introducción: La traqueostomía percutánea con dilatadores
(TPD) es un procedimiento electivo mínimamente invasivo para pacientes que
requieren ventilación mecánica prolongada.
Objetivo: Determinar la experiencia de la TPD realizada
por terapistas como practica bedside.
Métodos: Se realizó un estudio prospectivo
observacional del primero de julio del 2021 al primero de julio del 2022, en
pacientes con ARM prolongada. Las variables registradas fueron, APACHE II, días
de ARM previos a traqueostomia, tiempo del procedimiento, complicaciones, y
mortalidad.
Resultados: Ingresaron a UTI 387 pacientes, 251 (64.8 %)
requirieron ARM. De los pacientes ventilados 113 (45%) eran post-quirúrgicos y
138 (55%) clínicos. El APACHE II promedio de pacientes que necesito
traqueostomia fue de 22.6 con un riesgo de mortalidad del 40%. De los 251
pacientes ventilados 35 (13.9 %) requirieron traqueostomía (TQT) de las cuales
22 (62.9 %) fueron percutáneas y 13 (37.1%) quirúrgicas. Días previos de ARM a
TQT fue un promedio de 13 días (3-22). El tiempo de realización fue un promedio
de 10 minutos (8-12) (punción traqueal – introducción de la cánula), 21 (97.1%)
sin complicaciones transoperatorias, pacientes que presentaron enfisema
subcutáneo 0, neumotórax 0, rotura traqueal 0 dificultad de inserción de la
cánula 0. hemorragia atribuible al procedimiento 1. (hemorragia leve periostoma
no se evidencio sangrado copioso y se descartó lesión de grandes vasos.)
Conclusiones: La TPD es un procedimiento seguro, que tiene
ventajas sobre la traqueostomía quirúrgica en cuanto a rapidez, seguridad
costo-efectividad y posibilidad de efectuar a pie de cama, evitando riesgos de
traslado. Si bien no existe un determinado tiempo ideal de realización de TPD
se observó que el tiempo varía según la anatomía del paciente; sin embargo,
manejar un tiempo necesario depende del operador con la finalidad de evitar
complicaciones tempranas y tardías. Esta técnica de TPD se instauro en nuestro
servicio por la gran incidencia de pacientes internados neurocriticos que
demandan rehabilitación respiratoria lenta. Aunque se necesita un mayor tamaño
muestral, este trabajo proporciona una plataforma para subsiguientes estudios.
0212 SINDROME CARDIOPULMONAR
POR HANTAVIRUS. A PROPOSITO DE UN CASO
M Paz(1), S
Araoz(1), NB Pinello(1), NG Passo(1)
(1) Sanatorio 9 De Julio.
Introducción: El Hantavirus es una zoonosis producida por
un ARN virus y transmitida al hombre por roedores infectados que lo eliminan a
través de orina, saliva y excretas. La infección humana se transmite por la
inhalación de aerosoles, también hay casos de persona a persona. Predomina en
jóvenes de ambos sexos, siendo más frecuente en varones, trabajadores rurales y
practicantes de senderismo o camping.
Caso clínico: Paciente femenina de 33 años, antecedentes de
práctica de senderismo. Consulta por síndrome febril, mialgias, poli artralgias
y malestar general de una semana de evolución, acompañado de disnea moderada y
tos seca. Examen Físico: GCS 15/15, febril, taquipnea e hipotensión arterial.
Exámenes Complementarios: Laboratorio: Hb 17,5 Hto 52% GB 16330, PLT 44000 Ur
0,27 Crea 0,70 Iono 135/5,0/109 GOT 50 GPT 45 FAL 327 Bili Tot 0,28. TAC de
torax: engrosamiento del intersticio lobulillar con areas en vidrio esmerilado
en distribucion parcheada y derrame pleural basal posterior bilateral. Evolución:
En primeras 24 hs, progresa con Distress respiratorio severo, inestabilidad
hemodinámica y deterioro del sensorio. Se intuba y se conecta a ARM.
Gasometría: 6,92/82/16/-20/16/7%. Presentó paro cardiorrespiratorio 2 hs post
intubación, sin respuesta a reanimación. Se recibe diagnóstico de Hantavirus
por serología positiva con ATC IgM en sangre periférica a los 5 días.
Discusión: El hantavirus tiene una baja incidencia, el
Síndrome Cardiopulmonar por Hantavirus es una patología de alta mortalidad y en
la que no existe tratamiento específico, puede presentarse en brotes.
En Argentina se observó dos grandes brotes:
en 1996 (20 casos) en El Bolsón-San Carlos de Bariloche, Provincia de Río Negro
y recientemente en 2018-2019 (34 casos) en Epuyén, Provincia de Chubut.
En la provincia de Tucumán desde el año 2017
no se registraba ningún caso.
Conclusión: Es imprescindible la sospecha temprana de
esta enfermedad en los casos de síndromes febriles e insuficiencia respiratoria
sin otra causa, sobre todo en pacientes probablemente expuestos al virus. La
enfermedad se considera objeto de vigilancia intensificada y notificación
obligatoria.


N Montaño(1), P
Carrasco(2), P Schoon(3), L Benito(3), N Carbajal(3), P Anave(3), M Baron(3)
(1) Higa Dr Luis Guemes Haedo. (2) Higa Dr
Luis Guemes De Haedo. (3) Higa Guemes Haedo.
La tuberculosis es una enfermedad infectocontagiosa,
cuya asociación con inmunosupresión conlleva a un aumento de la
morbi-mortalidad. La presentación pulmonar que progresa a insuficiencia
respiratoria y requiere internación en UCI es poco frecuente, con una
mortalidad global del 33%; llegando al 81% en los pacientes que requieren
ventilación mecánica.
A continuación presentamos una descripción de
casos admitidos en una Unidad de Terapia Intensiva polivalente, durante el
periodo de pandemia de COVID-19 de Octubre /2021 hasta Agosto /2022 (Adjunto
Tabla 1).
Discusión: La bibliografía establece como una
complicación tardía, la insuficiencia ventilatoria en pacientes con
Tuberculosis pulmonar. Si los pacientes son diagnosticados precozmente y
reciben un tratamiento oportuno el riesgo disminuye.
En la serie de casos presentados los
pacientes no fueron diagnosticados oportunamente. Relacionamos este hecho a una
época pandémica de otra enfermedad emergente como el COVID 19, donde los
pacientes no acudieron en tiempo y forma a centros hospitalarios y muchos de
ellos abandonaron tratamiento.
Conclusión: El retraso en el diagnóstico y tratamiento
hizo que el riesgo de desarrollar insuficiencia ventilatoria aumentara con
respecto a años atrás encontrando un aumento de la mortalidad en pacientes con
Tuberculosis que no acudieron oportunamente a un centro hospitalario en una
época donde la reducción de la movilidad poblacional, además de medidas de
aislamiento y el temor de contraer una nueva enfermedad.

AL Ramirez Ayala(1),
J Ripoll(1)
(1) Fiorito.
Introducción: La Leptospirosis es una zoonosis de
distribución mundial causada por Leptospira interrogans. Siendo la enfermedad
de weil la complicación mas grave con alta tasa de morbi/mortalidad, su
compromiso respiratoria es del (40%). En Argentina las provincias con mayor
notificación son Entre Ríos, Santa Fe y Buenos Aires.
Objetivo: Describir la evolución y gravedad del caso
clínico.
Presentación de caso: Masculino de 28 años antecedente consumo de
cocaína y tabaquismo, Ingresa a clínica medica por síndrome febril, con
serologías para VHC,CHB VDRL,HIV,CMV,VEB(negativas); Asociado presenta
disfunciones orgánica mde tipo (hematológica/renal/hepática/coagulopatica),
Sedimento urinario patológico (hematuria microscópica) inician ATB (ampicilina
sulbactan), Se complementa con HNF COVID-19, Hemocultivox2 y Urocultivo
(negativos); Intercurre con IVA/hipotensión, ingresando a UTI por necesidad de
ARM y vasoactivos interpretándose como shock distributivo (séptico),
Realizándose TAC de tórax: evidencia infiltrado difuso bilateral con patrón
micronodulillar, persistiendo las disfunciones orgánicas y agregandose
(respiratoria/hemodinámica). Por nexo epidemiológico laboral (limpieza de
arroyo) se solicita prueba indirecta y directa para leptospirosis informándose
(positiva). En UTI requirió 1 ciclo de prono de 24 hrs., con mejoría del SDRA;
Intercurrencia infectologica: aspirado traqueal con Klebsiella Pneumoniae tipo
KPC y Acinetobacter Baumannii interpretándose como NAVM iniciando antibiótico
dirigido. Presenta buena evolución mejoría de las disfunciones, extubandose
electivamente, pasando a sala general. Previa realización de estudios de
control TAC y Ecografía abdominal.
Discusión: En pacientes sintomáticos las manifestaciones
son leves, graves e incluso letales. La leptospirosis grave (Enfermedad de
Weil) es la forma más severa de presentación, caracterizada por ictericia,
disfunción renal/vascular, el compromiso respiratorio puede clasificarse en
tipo 1. Leve a moderado (20-70%) con infiltrados pulmonares, ictericia y falla
renal, Tipo 2. Severa con ictericia, nefropatía, hemorragias (Enfermedad de
Weil) y muerte debida a falla renal, miocarditis o hemorragia masiva con
colapso vascular, Tipo 3 hemorragia pulmonar generalmente mortal sin ictericia,
nefropatía y otras hemorragias.
Conclusión: Las manifestaciones clínicas de Leptospirosis
a menudo dificulta su diagnóstico por lo cual es menester la anamnesis dirigida
a la posible exposición, el diagnóstico temprano permite un tratamiento
oportuno evitando mortalidad.


0215 Toxicidad por metformina:
presentación de un caso clínico
MA Balauz(1), M
Ducasa Torres(1), P Balmaceda(1), M Salazar(1), F Amieva(1), GE Ramos(1), V
Picolla(1), CB Cozzani(1)
(1) Hga Cosme Argerich.
Introducción: La metformina es pilar en el tratamiento de
la diabetes tipo 2, siendo utilizada en situaciones de insulino-resistencia. La
toxicidad, y en particular la acidosis láctica, es una complicación poco
frecuente, pero de elevada morbi-mortalidad sobre todo si se tienen en cuenta
factores de riesgo preexistentes.
Caso clínico: Presentamos un paciente de 59 años, con
antecedentes de DM 2, IAM e IRA, medicado con glimepirida, metformina,
furosemida, espironolactona, aspirina, carvedilol y atorvastatina, que ingresa
a UTI en contexto de gastroenteritis de 3 días de evolución complicando con
insuficiencia renal aguda sobre crónica, shock y acidosis metabólica a GAP
aumentado (40) e hiperlactacidemia de 91 mg/dl a su ingreso. Requirió ARM en
contexto de insuficiencia ventilatoria, deterioro del sensorio y shock, con
criterios de terapia de reemplazo renal de urgencia. Luego de la tercera sesión
de hemodiálisis presentó mejoría hemodinámica y del medio interno, logrando su
extubación y posterior egreso de la unidad de cuidados críticos.
Discusión: La metformina presenta 90% de excreción renal
sin metabolizar. Su uso en contexto de deterioro de la función renal se
encuentra desaconsejado ya que la disminución de su depuración aumenta el
riesgo de efectos adversos.
Bloquea la gluconeogénesis hepática
inhibiendo la cadena respiratoria mitocondrial, tanto induciendo la producción
de lactato como dificultando el clearence del mismo. En situaciones
patológicas, esto da lugar a dos cuadros: la acidosis láctica inducida por
metformina, o bien, acidosis láctica asociada a metformina.
Conclusión: Frente a un paciente con acidosis metabólica
severa a gap aumentado desproporcionada para la clínica inicial, se continuó
con el algoritmo diagnóstico. Sospechando una etiología tóxica se solicitó
dosaje de salicilemia resultando negativo, descartando también la presencia de
cristales en orina como indicadores de intoxicación con alcoholes pesados.
En contexto de un paciente medicado con
hipoglucemiantes orales, que complica con acidosis láctica severa, en el cual
se observó franca mejoría con la temprana TRR, este evento podría interpretarse
como asociado al consumo de metformina. Esta asociación requiere un alto índice
de sospecha. Su diagnóstico generalmente es de exclusión, ya que el dosaje de
la misma no se encuentra disponible en nuestro medio.
G Yossa(1)
(1) Aleman.
Introducción: Un catéter venoso central (CVC) es de amplio
uso en terapia intensiva pero puede presentar complicaciones como las de causa
infecciosa.
Existen trabajos que demuestran la relación
entre el sitio de inserción y la incidencia de infecciones(1). Sin embargo, hay
controversia respecto del rol preventivo de la colocación bajo guía ecográfica
respecto al desarrollo de infecciones (2). Existe evidencia de que disminuye
las complicaciones mecánicas respecto a la cateterización no ecoguiada(3-4-5).
En el presente estudio se evaluó la
asociación entre la colocación de CVC bajo guia ecografica y el desarrollo de
BAC
Materiales y métodos: Se analizó en una cohorte retrospectiva de
pacientes adultos admitidos a la UCI en quienes se colocó al menos un CVC en el
periodo entre el 1 de enero de 2019 y el 31 de junio de 2022. Se registraron
variables clínicas, las relativas al CVC y los eventos de infecciones
relacionados. La asociación entre la colocación de CVC ecoguiado y BAC se
evaluó mediante regresión logística, para la cual se identificaron variables
detectadas durante el análisis univariado.
Resultados: Se incluyó un total de 1926 pacientes que
tuvieron al menos 1 CVC durante su internación. Las principales características
de los pacientes incluidos y del uso de catéteres se resumen en la tabla 1 y 2.
Si bien en el análisis crudo, el uso de ecografía para la colocación de los
catéteres se asoció a un mayor riesgo de desarrollo de BAC (OR 1,87, IC 95%
1,30 - 2,69, p= <0,001), luego de realizar un ajuste multivariado por la
localización anatómica, la colocación dentro o fuera de la UTI y los días de
permanencia del CVC, no se evidenció una asociación significativa con riesgo de
BAC. (OR 1,34, IC95% 0,87 - 2,09, p= 0,191).
Conclusión: En este estudio no se halló asociación
estadísticamente significativa entre la colocación mediante ecografía y el
desarrollo de BAC.
0217 ENFERMEDAD DE POMPE,
ENFERMEDAD RARA DEL ALMACENAMIENTO DE GLUCOGENO
P Zuleta Chambi(1), A Bonilla(1), E Polo(1), J
Rivadeneira(1)
(1) Hospital Del Trauma Dr Federico Abete.
Introducción: La forma de inicio en el adulto es muy rara
por lo que se puede confundir con otras miopatías inflamatorias, actualmente no
contamos con datos epidemiológico en argentina, reportándose casos
confirmatorios con resultados de tratamiento y buena evolución en países
vecinos, En el 2012, un estudio reportó que solo se tenían 88 pacientes 10 con
esta enfermedad en toda América Latina. Con una incidencia entre 1:14.000 y
1:300.000, dependiendo del área geográfica estudiada, siendo la forma infantil
la más representativa
Presentación del caso: Paciente femenina de 71 años con antecedentes
de polimiositis diagnosticada el 2006, hipotiroidismo, en tratamiento con
metilprednisolona, metotrexate, levotiroxina ingresa a unidad de terapia
intensiva en post paro respiratorio requiriendo de ventilación mecánica
invasiva, cumplió tratamiento por neumonía de la comunidad, extubacion fallida,
por insuficiencia ventilatoria, se consideró progresión de patología de base
polimiositis, con estudios complementarios dando negativos para agudización, no
llegando a la extubacion se realiza traqueostomia percutánea, intentos fallidos
de destete del ventilador mecánico, se buscan patologías diferenciales sobre
miopatías inflamatorias, se realiza tamización para enfermedad de pompe con
gota de sangre en papel filtro la cual resultado fue positivo de alfa
glucosidasa acida 93% en espera de confirmación genética e inicio del
tratamiento enzimático para poder lograr desvincular del ventilador,
considerando a la paciente como ventilada crónica.
Discusión: Los temas a discusión: definición de la enfermedad
de pompe, como llegar al diagnóstico confirmatorio, fallas en la extubacion y
desvinculación, tratamiento dirigido.
Conclusión: Enfermedad de pompe puede pasar desapercibida
si no se tiene en cuenta dentro de los diagnósticos diferenciales de las miopatías
inflamatorias, ya que puede presentar manifestaciones clínicas similares con
debilidad muscular proximal. Causando la acumulación de glucógeno en tejido
muscular estriado, cardiaco y liso. Su detección temprana es de importancia
para iniciar tratamiento detener el deterioro clínico y evitar las
complicaciones derivadas mejorando la calidad de vida de los pacientes, siendo
el primer caso de enfermedad de pompe tardio del adulto en argentina


0218 Sindrome Inflamatorio
Multisistémico en el adulto asociado a COVID19
P Boschero(1), M
Acquafredda(2), G Tombolini(2), S Gonzalez(2)
(1) Hospital De La Asociación Medica” Dr.
Felipe Glasman”. (2) Hospital De La Asociación Medica “dr. Felipe Glasman”.
Introducción: El síndrome de inflamación multisistémico
secundario a COVID19 (SIM) es una entidad poco común de presentación pediátrica
con una incidencia menor a 2 casos cada 100.000 habitantes en mayores de 20
años.
Presentación del caso: Paciente masculino de 26 años de edad con
antecedentes de infección por COVID19 leve 30 días previos a la consulta;
vacunado con primera dosis de vacuna “AztraZeneca” 20 días antes; consulta por
fiebre persistente de 4 días de evolución asociado a cefalea, vómitos, dolor
abdominal y diarrea. PCR para sarscov2 negativa. . Ecografía abdominal:
hallazgos compatibles con patología apendicular. Con diagnóstico presuntivo de
apendicitis aguda se realizó apendicectomía sin características macroscópicas
sugerentes de inflamación.
Evolucionó días posteriores con shock
cardiogénico, que requirió asistencia ventilatoria mecánica y soporte con
noradrenalina y dobutamina . Se realizó ecocardiograma que mostró una función
sistólica severamente deteriorada (Fey 20%), asociado a marcadores
inflamatorios elevados (DD, PCR, LDH, VSG) con cultivos negativos.
Con diagnóstico presuntivo de SIM, se realizó
infusión con inmunoglobulinas IV a razón de 2mg/Kg y tres pulsos de
Metilprednisolona 1g/día.
Presentó mejoría clínica y ecocardiografica a
las 48hs con Fey 62%. Lo que permitió la suspensión de drogas vasoactivas y
weaning.
4 días después pasa a sala de Clínica con Fey
70%.
Discusión: Es una complicación poco frecuente de COVID
19, descripto originalmente en población pediátrica, cuyo reconocimiento precoz
resulta fundamental para lograr un adecuado tratamiento.
La misma cursa con síntomas que van desde
afecciones cutáneas y gastrointestinales leves, un cuadro similar a la
enfermedad de Kawasaki y en sus formas más severas disfunción cardiaca y shock,
existiendo una superposición de estos fenotipos
Criterios diagnósticos para CDC y OMS (Ver
Tabla en imagen)
Su tratamiento consiste en soporte
hemodinámico, administración de inmunoglobulinas intravenosas y, según
gravedad, el uso de corticoides sistémicos a altas dosis; con terapias de
segunda línea consistentes en fármacos inmunomoduladores.
Conclusión: Se debe tener un alto índice de sospecha ante
un estado hiperinflamatorio con disfunción de órganos extrapulmonar que se da 4
semanas posteriores a la infección por sars cov 2.

0220 CRIPTOCOCOSIS MENÍNGEA EN
PACIENTE CON USO CRONICO DE CORTICOIDES: REPORTE DE CASO
OF Ferreira Aban(1),
CF Chavez(2), R Dominguez(2), J Cardozo(2), L Soliz(2), JC Galarza(2), MB
Vazquez(2), C Pozo(2), N Grubissich(2), D Pina(2)
(1) Cesar Milstein. (2) Hospital Cesar
Milstein.
Resumen: La criptococosis una micosis causada por el
complejo Criptococcus Neoformans, que es parte de la microbiota humana y
responsable del 8% de las micosis invasoras, con una incidencia de un caso por
100.000 individuos/año en no HIV. Una tasa de mortalidad de aproximadamente el
20%, presentándose en mayor frecuencia en pacientes HIV y trasplante de órganos
sólidos, y menor medida de corticoterapia, LES, entre otros.
Presentación del caso: Femenina de 64 años con antecedentes de TVP y
consumo crónico de corticoides por dolor articular. Ingresa a otro nosocomio
por 48 hs con deterioro neurológico asociado fiebre, se realizó punción lumbar
compatible con meningitis, iniciando antibiótico empírico. Al culminarlo
progresa con nuevos registros febriles y plejia Facio-braquiocrural derecha,
con TC de encéfalo sin evidencia de lesiones agudas, se aumenta esquema a vancomicina
+ aciclovir. A los 17 días del inicio, ingresa a nuestra unidad, GW 9/15
requiriendo ARM, se realiza nueva PL. Se dialoga con servicio de microbiología
para realizar tinta china donde evidencia imagen levaduriforme compatibles con
Criptococcus Neoformans (foto 1), se rota a anfotericina B liposomal +
fluconazol, test HIV y perfil reumatológico con resultado negativo. Fallece por
fallo orgánico multiple.
Discusión: La infección por criptococcus se produce por
inhalación de levaduras presentes en el ambiente que han perdido la capsula,
con posibilidad de diseminación en los inmunocomprometidos, presentándose como
meningoencefalitis, infección pulmonar aguda o forma sistémica grave, su
diagnóstico se realiza mediante el cultivo de la muestra LCR, sensibilidad del
75- 90% en no HIV. El tratamiento depende a la forma clínica y gravedad,
controlando la respuesta terapéutica con cultivo del LCR y monitorizando la
presión de apertura, no solo como parámetro de mala respuesta terapéutica, si
no por la hipertensión endocraneana.
Conclusión: La criptococosis meníngea va en aumento,
sobre todo en pacientes no HIV, debiendo considerarlo como patógeno, en
meningitis sin adecuada respuesta clínica a los antibióticos, sobre todo en
paciente con uso de corticoides. Esta posibilidad diagnostica, debe abrir las
puertas la sospecha ante el aumento de casos, para evitar demoras en el inicio
de antifúngicos, y disminuir la mortalidad del paciente.

D Carelli(1), M
Antonini(1), R Lema(1)
(1) Juan A. Fernández.
Introducción: Durante la transición de la vía enteral a la
vía oral, es frecuente la presencia de inadecuación al requerimiento calórico
en los pacientes críticos post extubación, lo que conlleva a un elevado riesgo
de malnutrición.
Objetivos: Determinar la adecuación al requerimiento
calórico en pacientes críticos en la Unidad de Cuidados Intensivos que se
encuentran en transición alimentaria hacia vía oral y determinar el motivo de
finalización de la nutrición enteral.
Materiales y métodos: Se calculó la media del porcentaje de
adecuación al requerimiento calórico a través de registro visual previo y
posterior a la ingesta diaria, y mediante el control diario del volumen
infundido por bomba de infusión continua para la vía enteral. Se determinó la
frecuencia del motivo de finalización de la nutrición enteral según el registro
de la historia clínica.
Resultados: La muestra inicial quedó conformada por 28
pacientes críticos mayores de 18 años post extubación en transición a la vía
oral. Los pacientes se evaluaron los días 1, 3, 5, 7 y al alta. La media del
porcentaje de adecuación calórica al alta fue del 59% y 48,5% para la vía oral
y nutrición enteral, respectivamente. El principal motivo de finalización del
soporte nutricional fue por indicación médica.
Conclusiones: A medida que transcurren los días de
internación, los pacientes post extubación aumentan la adecuación del
requerimiento calórico pero de forma lenta y progresiva, con tendencia a ser
desprovistos de la nutrición enteral de manera precoz por indicación médica.
Palabras clave: Transición alimentaria, paciente crítico,
adecuación al requerimiento calórico, post extubación.


0223 NECROSIS ESOFÁGICA AGUDA
EN PACIENTE CRÍTICAMENTE ENFERMO: REPORTE DE CASO
CF Chavez(1), F
Ferreira(2), L Soliz(2), J Cardozo(2), R Dominguez(2), MB Vazquez(2), JC Galarza(2),
C Pozo(2), N Grubissich(2), D Pina(2)
(1) Cesar Milstein. (2) Hospital Cesar
Milstein.
Resumen: La necrosis esofágica aguda (ENA), conocida
como “esófago negro”, es un trastorno clínico poco común, prevalencia de 0.2%
con una tasa de mortalidad del 30 al 50%. Caracterizado por hallazgos
endoscópicos que muestran una coloración negruzca de la mucosa esofágica con
transición abrupta a nivel de la unión esofagogástrica. Su etiopatogenia es
poco clara, siendo las teorías más aceptadas: isquemia local, compromiso de las
defensas de las mucosas, lesión corrosiva no caustica de contenido gástrico.
Presentación del caso: Masculino de 70 años con antecedentes de
BCRI, FAARV ACO, ACV cardioembólico (reemplazo valvular aórtico mecánico).
Consulta a guardia externa por cuadro de hipotensión y registros febriles. Se
realiza hemocultivo, urocultivo e inicia antibióticoterapia. Evoluciona con
shock séptico a probable foco urinario e ingresa a Unidad crítica con
requerimientos de ARM asociado a falla renal AKIN 3 e inicia TSR, SOFA 6 (CV4
R2). Se indica corticoides dosis shock (noradrenalina 0,6 mcg/kg/min)
protección gástrica con IBP, se ajusta terapia antibiótica según sensibilidad
(hemocultivo 2/2 KPMBL+; urocultivo KPMBL+). Intercurre con hemorragia digestiva
alta, se realiza veda, evidenciando lesiones en esófago (figura A y B).
Evoluciona de manera desfavorable, culminando en óbito.
Discusión: La ENA es una patología sumamente rara, cuya
patogénesis no se ha identificado hasta ahora, pero se la asocia con estados de
hipoperfusión tisular y con antecedentes de patologías cardiovasculares, shock,
sepsis, diabetes mellitus, entre otros. El tratamiento se enfoca en tratar la
patología de base con adecuado sostén, inhibición de ácidos gástricos con IBP.
Se debe iniciar tratamiento antimicrobiano cuando los cultivos de líquidos
esofágicos son positivos.
Conclusión: El ENA es más frecuente en hombres que en
mujeres en pacientes con múltiples factores de riesgo antes mencionados, con
una mortalidad estimada mayor al 50% a pesar del tratamiento específico. La
importancia de estos casos es considerar métodos de estudios complementarios
del tubo digestivo en pacientes con shock septico.

0224 NEUMONÍA EOSINOFÍLICA SECUNDARIA A DAPTOMICINA
SG Pello(1), ML Ortiz(1),
A Couso(1), AB Canedo Bermudez(1), SS Benavides Mariño(1), P Balmaceda(1), MA
Ducasa Torres(1), MF Amieva(1), V Picolla(1), GE Ramos(1), CB Cozzani(1)
(1) Cosme Argerich.
Introducción: La Daptomicina es un lipopéptido antimicrobiano
con actividad contra organismos grampositivos, incluidos patógenos resistentes.
Dicho fármaco es uno de los más implicados en la neumonía eosinofílica inducida
por fármacos.
Presentamos un caso de neumonía eosinofílica,
la cual se distingue por la presencia de infiltrados eosinofílicos pulmonares y
eosinofilia periférica, como efecto adverso del uso de Daptomicina.
Presentación del caso: Paciente masculino de 33 años, con
antecedentes de consumo problemático de fentanilo. Cursó internación por
Neumonía bilateral cavitada con rescate en hemocultivos 2/2 Staphylococcus
aureus OXA- R y Endocarditis infecciona derecha, en tratamiento con
Vancomicina endovenosa. Evolucionó con empiema bilateral con rescate en líquido
pleural de Enterococcus faecium Vancomicina resistente. Se realizó
cirugía toracoscópica asistida por video con decorticación pleural e inició
tratamiento antibiótico con Daptomicina. Evolucionó tórpidamente, febril
persistente, con requerimiento de oxígeno suplementario. En tomografía de tórax
se evidenció infiltrado bilateral en 4 cuadrantes, de tipo consolidativo,
asociado a eosinofilia. Se interpretó cuadro como Neumonía eosinofílica
asociada a tratamiento con Daptomicina, por lo cual suspendió dicho fármaco e
inició tratamiento con metilprednisolona con posterior mejoría clínica y
radiológica.
Discusión: Los reportes de casos de Neumonía
eosinofílica asociado a uso de Daptomicina han crecido en los últimos años y se
correlaciona al aumento del uso de dicha droga. Para el diagnóstico de esta
entidad se describen criterios de inclusión: exposición a Daptomicina, fiebre,
disnea o aumento de los requerimientos de oxigenoterapia o necesidad de ARM,
nuevos infiltrados a nivel imagenológico, mejoría clínica al discontinuar el
tratamiento.
Conclusión: En el presente caso, tanto los criterios
clínicos, la eosinofilia, la asocición con el antibiótico empleado y la
consiguiente mejoría clínica evidenciada tras la suspensión del mismo, fueron
compatibles con Neumonía eosinofílica secundaria a Daptomicina. El
reconocimiento temprano y el tratamiento apropiado son determinantes en la
evolución de esta complicación.
D Vasquez(24), R
Giannoni(1), A Salvatierra(2), K Cisneros(3), D Lafosse(4), F Escobar(5), M
Montenegro(6), P Juárez(7), L Visani(8), V Mandich(9), E Barrozo(10), M
Kirschbaum(11), A Das Neves(12), MF Valenti(13), MC Canseco(14), I Romero(15),
P Macharé(16), A Marquez(17), E Rodriguez(18), C Palacio(19), L
Rapela(20), Amillateg
(1) Hospital Regional Ramón Carrillo. (2)
Hospital Del Este “Eva Perón”. (3) Sanatorio Antártida. (4) Hospital Materno
Infantil Dr. F Escardó. (5) Fundación Valle Del Lili. (6) Hospital Materno
Infantil Ramón Sardá. (7) Hospital De La Madre Y El Niño. (8) Hospital Cuenca
Alta Néstor Kirchner. (9) Hospital Santojanni. (10) Maternidad Provincial
Teresita Baigorria. (11) Sanatorio Finochietto. (12) Hospital Interzonal
General De Agudos Gral. San Martín. (13) Sociedad Argentina De Terapia
Intensiva. (14) 15. Instituto De Maternidad Y Ginecología Nuestra Señora De Las
Mercedes. (15) Sanatorio Güemes. (16) Hospital Mi Pueblo. (17) Hospital
Municipal De Morón. (18) Hospital Simplemente Evita. (19) Sanatorio Itoiz. (20)
Hospital Municipal Del Carmen. (21) Hospital Provincial Del Centenario. (22)
Hospital Mariano Y Luciano De La Vega. (23) Sanatorio Anchorena San Martín.
(24) Sanatorio Anchorena.
Introducción: La evidencia disponible sobre pacientes
obstétricas con requerimiento de soporte ventilatorio avanzado y el impacto de
la finalización del embarazo (FE) sobre los parámetros respiratorios es
retrospectiva, escasa y controvertida.
Objetivo: Analizar parámetros respiratorios, factores
de riesgo para ventilación mecánica invasiva (VMI) e impacto de la FE sobre la
mecánica pulmonar/oxigenación y evolución materno-fetal-neonatal.
Materiales y métodos: Estudio de cohorte prospectivo multicéntrico.
Población: pacientes embarazadas/puérperas con neumonía por COVID-19 que
ingresaron a UTIs de Argentina y Colombia requiriendo soporte ventilatorio
avanzado (20/3/21-31/12/21).
Resultados: 91 pacientes de 31±6 años ingresaron a 21
UTIs. Edad gestacional 29.2±4.9 semanas- 63(69%) antepartum. Máximo soporte
ventilatorio recibido: VMI (69;76%), cánula nasal de alto flujo (CNAF=20;
46.5%) y ventilación no invasiva (VNI=2, 2.2%). Parámetros respiratorios
basales en las pacientes embarazadas: presión plateau (PP) 24.3±4.5, driving
pressure (DP) 12.5±3.3, compliance estática (CE) 31[26-40] y PaO2/FiO2
142[110-176]. La PEEP programada fue 11.1 ± 2.7. Parámetros respiratorios antes
y luego del parto (≤2h y 24h), respectivamente: PEEP (11±3, 12±4 y 11±2;p0.8);
PP (25.6±6.6, 24±6.7 y 24.6±5.2; p0.59); DP (13.6±4.2, 12.9±3.9 y
13±4.4;p0.69); CE (28[22.5-39], 30[24.5-44] y 30[24.5-44];p0.058) y PaO2/FiO2
(134[100-230], 168[136-185] y 192[132-232.5];p0.022)(Fig.1).El único factor de
riesgo para VMI fue SOFA24(OR 1.97[1.29-2.99]p0.001). Las indicaciones de FE
fueron: maternas (43/71; 60.5%), materno-fetales (21/71; 29.5%) y fetales
(7/71; 9.9%). Los factores de riesgo para mortalidad materna fueron la presencia
de comorbilidades (OR 4.15[1.212- 14.20];p0.023) y el índice de masa
corporal(IMC)(OR 1.10[1.006-1.204];p0.037). Los factores de riesgo para
mortalidad fetal/neonatal fueron edad gestacional al momento de FE (OR
0.67[0.52-0.86]p0.002) y SOFA24 (OR 1.53[1.13-2.08]p0.006).
Conclusiones: Contrariamente a lo que supondrían los
cambios fisiológicos del embarazo, la mecánica pulmonar de las pacientes
embarazadas fue similar a la de la población general con COVID-19. La razón
principal para finalizar el embarazo fue materna, sin embargo, la IE no se
asoció a ningún cambio significativo en la mecánica pulmonar, solo evidenciando
una mejoría en la PaO2/FiO2. El único factor de riesgo para VMI fue el SOFA24.
La mortalidad materna se asoció independientemente con el IMC y la presencia de
comorbilidades. La mortalidad fetal/neonatal se asoció independientemente con
el SOFA24 y la edad gestacional al parto.

0226 SINDROME DE WUNDERLICH,
UNA CAUSA POCO COMÚN DE SHOCK. REPORTE DE UN CASO
L Soliz(1), J Cardozo(1),
R Dominguez(1), MB Vazquez(1), C Chavez(1), F Ferreira(1), JC Galarza(1), C
Pozo(1), N Grubissich(1), D Pina(1)
(1) Hospital Cesar Milstein.
Introducción: El síndrome de Wunderlich (SW) es una entidad
clínica poco frecuente del cual se describieron 550 casos en los últimos 90
años, con alta mortalidad (30%) y predominio en sexo femenino (61%),
caracterizada por aparición repentina de hemorragia espontánea no traumática en
la región subcapsular renal y retroperitoneal.
Presentación del caso: Femenino de 82 años, que cursaba internación
prolongada en sala general, con reciente diagnóstico de Linfoma no Hodgkin,
quien en su día 10 de tratamiento quimioterápico (R-CHOP) intercurre con dolor
lumbar de aparición súbita, distensión abdominal, disnea, palpitaciones e
inestabilidad hemodinámica, por lo que ingresa a UTI. Una vez lograda la
estabilización hemodinámica, se solicita TAC abdomino pélvica, cuyo informe
inicial reporta hematoma perirrenal izquierdo. (Figura 1.)
Se solicita reevaluación por equipo
quirúrgico y eventual intervención inmediata, conducta que no es aceptada por
familiares. Ante esta situación, se opta por tratamiento conservador,
optimizando estado hemodinámico. Se continúa seguimiento en el tiempo mediante
control por imágenes.
Discusión: El síndrome de Wunderlich o hemorragia renal
espontánea es una entidad clínica infrecuente, caracterizada por la aparición
súbita de hemorragia espontanea no traumática en la región subcapsular renal y
retroperitoneal. Este síndrome típicamente se caracteriza por la tríada de Lenk
-dolor agudo en flanco, masa palpable abdominal y shock hipovolémico. Se
presenta de manera atípica en 70 a 80% de los casos y hasta en un 60% la
entidad patológica subyacente es la neoplasia.
Una vez determinada la etiología renal de la
hemorragia, el manejo definitivo de elección es el abordaje quirúrgico
(nefrectomía) o embolización angiográfica selectiva. En pacientes clínicamente
estables, el tratamiento conservador con imágenes de seguimiento puede ser una
opción razonable, pudiendo evitar una intervención quirúrgica innecesaria.
Conclusión: El síndrome de Wunderlich es una causa de
presentación inusual de shock. El diagnóstico temprano puede lograrse mediante
una evaluación clínica precisa y estudios complementarios por imágenes
apropiados. (Figura 2.)

F Morales(1), M
Córdova(2), A Cucci, M Gardeazabal(2), I Parodi, C Logiodice, J Villca, F
Fernández Garcia, L Milanesio, F Iglesias, A Carrera, G Saenz, A Toro, L Tumino(2),
CI Loudet
(1) San Martín De La Plata. (2) San Martin.
Introducción: El síndrome hepato-pulmonar es una
complicación vascular pulmonar de la enfermedad hepática terminal; se
caracteriza por dilataciones vasculares intrapulmonares y cortocircuitos, con
deterioro del intercambio gaseoso. Su diagnóstico y terapéutica es un desafío
si no existe una alta sospecha.
Presentación del caso: Paciente femenina de 16 años sin
antecedentes, ingresa a sala de clínica por sepsis con foco desconocido; al 4°
día presenta fiebre, deterioro de la oxigenación e infiltrados bilaterales,
patrón de vidrio esmerilado en tomografía torácica; pasa a UTI. Al ingreso
presenta insuficiencia respiratoria, requerimiento de ARM con inestabilidad
hemodinámica: se interpreta como sepsis a foco pulmonar; COVID negativo.
También presenta plaquetopenia, hiperbilirrubinemia e hipoprotrombinemia.
A las 72 horas persisten alteraciones del
hepatograma; en ecografía se observa hígado de contornos irregulares,
disminución de tamaño y eco-respuesta heterogénea difusa. Circulación colateral
en epiplón menor y retroperitoneal con esplenomegalia homogénea. En Doppler
espleno-portal: dilataciones varicosas espleno-renales, gastroepiploicas y
retroperitoneales; vena porta de 12 mm de calibre a nivel de hilio hepático con
afinamiento distal, flujo de dirección hepatógena, índice de resistencia 0.7;
asociado a Factor VII 94%. Se diagnostica cirrosis de origen no filiado.
Servicio de Hepatología solicita serologías y otros estudios para búsqueda etiológica.
Al día 16 de internación, CONTINÚA EN VM SIN
DIAGNÓSTICO ETIOLOGICO, progresa con insuficiencia renal y SDRA: sin respuesta
a PEEP ni prono (PO2:50; Gradiente A-a 598.4). Monitoreo invasivo en arteria
pulmonar: hipertensión pulmonar, porcentaje de 100% shunt (fórmula QS/QT). Se
realiza ecocardiograma: normal. Se realiza test de burbuja: positivo a partir
de 4-5 latidos, descartándose shunt intracardiaco. Se interpreta como Síndrome
hepato-pulmonar, solicitándose derivación para trasplante hepático. La paciente
fallece a los 19 días de internación con fallo multiorgánico.
Discusión: El cuadro de hipoxemia refractaria condujo a
la pesquisa en profundidad del mecanismo respectivo, llevando a realizar
ecocardiograma con test de burbujas y cálculo de shunt. La presencia de shunt
intrapulmonar asociado a la cirrosis permitió el diagnóstico.
Conclusión: El síndrome hepato-pulmonar es una
complicación rara y se asocia con alta mortalidad. El trasplante de hígado es
la única opción terapéutica; el diagnóstico precoz permite acelerar la
solicitud y brindar una opción terapéutica.

NA Issoglio(1), NI Carrizo(2), MM Filippi(2),
MN Kinderknech(2), V Fugas(2)
(1) J. M. Cullen Santa Fe. (2) Hospital Jm
Cullen.
Introducción: El Accidente cerebrovascular hemorrágico
tiene como entidad a la hemorragia subaracnoidea (HSA) no traumática, esta presenta
complicaciones graves como distintos grados secuelas neurológicas hasta la
muerte del paciente.
Objetivo: Evaluar la evolución de los pacientes con
diagnóstico de HSA no traumática.
Materiales y métodos: Estudio de prevalencia, en pacientes ingresados
de enero de 2018 a marzo de 2022 en la unidad de terapia intensiva del Hospital
J. M. Cullen, de edad mayor a 18 años. Se describieron las características de
la población y se compararon las razones de prevalencia mediante el test del
chi-cuadrado con un nivel de significancia del 95% (p<0,05).
Resultados: Del total de 40 pacientes, el 62% fue de sexo
femenino y la mediana de edad de 47 años (24-75). Los síntomas más frecuentes
fueron cefalea (60%), alteración del estado de conciencia (28%) y foco neurológico
(10%). Las complicaciones más frecuentes fueron hidrocefalia (35%) y vasoespamo
(32%). La mortalidad fue del 50%. En tabla n1 se detallan las características
de los pacientes con HSA. La causa predominante fue aneurismática (80%) siendo
17% de origen múltiple. La probabilidad de presentar aneurisma múltiple fue
mayor en sexo femenino (RP 1,87; p 0,35). La probabilidad de presentar peor
evolución fue en las de origen de arteria cerebral anterior (ACA) en
comparación con arteria cerebral media (ACM) (RP1,60; p0,62), y similar en
arteria cerebral posterior (ACP) en comparación con ACM (RP0,93; p0,62). Se
observa una peor evolución en pacientes con Hunt y Hess (HH) 5 en comparación
con los de HH 1 a 4 (RP2,08; p0,08) tabla n2. Se observa menor morbilidad también
al presentar menor Fisher 2(F2) en comparación con F4 (RP0, 34; p0,2) y F3 en
comparación con F4 (RP0,64; p0,2) tabla n2.
Conclusión: Se observó una evolución desfavorable en
pacientes con aneurisma de ACA y que presentaron HH de 5. La probabilidad de
tener mejor evolución es con Fisher 2. Contrario a la literatura general, en
nuestro servicio predominaban los aneurismas de ACM.


0229 Incidencia de delirium en
una Unidad de Cuidados Intensivos
C Garcia Laplaza(1),
C Berrondo(1), E Monteverde(1)
(1) Gutierrez.
Introducción: El delirium es una disfunción cerebral de
inicio agudo y de carácter fluctuante secundaria a una patología o a su
tratamiento. Se ha demostrado, tanto en adultos como en pediatría, que esta
entidad aumenta la morbimortalidad de los pacientes en unidades de cuidados
intensivos. En pediatría la incidencia informada es variable, asociada a la
reciente validación de escalas para screening, diagnóstico y seguimiento. Las
últimas guías de práctica clínica sugieren la pesquisa sistemática en todos los
pacientes, ya que es una patología subdiagnosticada en las Unidades de Cuidados
Intensivos Pediátricas (UCIP).
Objetivo: Determinar la incidencia de delirium en una
UCIP.
Materiales y métodos: El estudio se lleva a cabo en una UCIP polivalente con aproximadamente
300 egresos anuales durante un período de 6 meses. Las herramientas utilizadas
para el screening diario de delirium fueron Preschool Confusion Assessment
Method for the Intensive Care Unit (psCAM-ICU) para pacientes menores de 5
años, Pediatric Confusion Assessment Method for the Intensive Care Unit
(pCAM-ICU) para mayores de 5 años y Cornell Assessment of Pediatric Delirium
(CAPD) para pacientes con retraso neurocognitivo.
Resultados: Se incluyeron 158 pacientes. Se identificaron
14 participantes con screening positivo: 8.86% (IC95% 4.9-14.4),
correspondiendo a una incidencia de 9.16 casos/1000 días-paciente en UCIP
(IC95% 5.0-15.3). De estos 14 pacientes, 6 tuvieron delirium hipoactivo (42%),
6 mixto (42%) y 2 hiperactivo (14%). El tiempo de duración promedio del
delirium en esta serie fue de 2 días (rango de 1 a 4 días). La presencia de
delirium se asoció con patología respiratoria como motivo de ingreso (RR 2.1),
mayor severidad estimada por PIM3, estadía más prolongada en UCIP y mayor
requerimiento de ventilación mecánica invasiva (RR 1.65) y no invasiva (RR
2.47). Si bien no se hallaron asociaciones estadísticamente significativas con
drogas utilizadas para analgosedación, en los pacientes con screening positivo
se observaron dosis acumuladas más altas de fentanilo, midazolam, clonidina y
dexmedetomidina.
Conclusiones: El delirium es una patología prevalente en
las UCIP. Es necesario realizar una pesquisa sistemática para evitar el
subdiagnóstico y mejorar el pronóstico de estos pacientes.
D Moretti(1), CA
Luchitta(1), DH Bagilet(1), NS Rocchetti(1), SP Gattino(1), MD Ré(1), S
Diodati(1), CJ Settecase(1)
(1) Hospital Escuela Eva Perón.
Introducción: En la unidad de cuidados intensivos (UCI), la
identificación de los pacientes con riesgo nutricional (RN) alto permitiría
potencialmente obtener el máximo beneficio de la terapia nutricional artificial
optimizada en dicha población. La pandemia de COVID-19 provocó un aumento dramático de ingresos en la
UCI debido al síndrome respiratorio agudo severo. La puntuación NUTRIC (con
IL-6) y sus variantes NUTRICm (sin IL-6) y NUTRICpcr (PCR en lugar de IL-6) se
propusieron para valorar el RN específicamente en críticos. Este estudio tuvo
como objetivo comparar estos escores para la valoración del RN en pacientes
críticos ventilados por COVID-19.
Material y métodos: Estudio prospectivo, observacional. Se
incluyeron pacientes >18 años, ventilados con COVID-19 y >72horas de
internación. Los datos de los pacientes se compararon entre el RN alto y bajo
del NUTRIC, NUTRICpcr y NUTRICm mediante los test Chi-cuadrado, Fisher,
t-Student o Wilcoxon. La discriminación de la mortalidad se realizó por
regresión logística en función del AUC ROC de cada escore. El acuerdo en la
clasificación y la comparación del alto riesgo nutricional entre NUTRIC,
NUTRICpcr y NUTRICm se analizó mediante la prueba de Kappa y la prueba
Chi-cuadrado.
Resultados: Se analizaron 418 pacientes. La mediana (RIQ)
de edad y del APACHE II fue: 54 años (6-61) y 13 puntos (10-19). Fallecieron en
UCI el 79%. La mediana (RIQ) en puntos del NUTRIC fue: 3 (2-4), del NUTRICpcr:
3 (2-4) y del NUTRICm 3 (3-5). El AUCROC (IC95%) del NUTRIC, NUTRICm y
NUTRICpcr para discriminar mortalidad fue: 0.661 (0.598-0.724), 0.659
(0.596-0.722) y 0.635 (0.572-0.697). El índice kappa fue: 0,8461 (coincidencia
95,7%) entre NUTRIC y NUTRICpcr, 0,7349 (coincidencia 91,9 %) entre NUTRIC y
NUTRICm y 0,8841 (coincidencia 96,2%) entre NUTRICm y NUTRICpcr. El porcentaje
de pacientes clasificados como alto RN mostro diferencias significativas entre
NUTRIC y NUTRICm (14,6% vs 22,7%, p 0,0033) (Figura 1).
Conclusión: En pacientes críticos ventilados con
COVID-19, los tres escores de riesgo nutricional estudiados describen la
población y discriminan la mortalidad en forma similar. Si bien concuerdan
entre sí, la clasificación del RN alto varía según cuál de ellos se utilice,
con una mayor prevalencia con el NUTRICm.

0231 PUNCIÓN TRANS-ORBITAL COMO MANIOBRA DE RESCATE
L Flores Trusso(1), ML
Campassi(2), F Repetto(2), D Banegas(2), G Gomez(2), B Tiseyra(2), I
Ramírez(2), N Picard(2), C Fauez
(1) Clínica Lpf. (2) Lpf.
Introducción: El acceso de emergencia al sistema
ventricular a veces es necesario para el tratamiento de la presión
intracraneal. Un procedimiento descrito en la literatura, es un abordaje
transorbitario realizado con una aguja espinal.
Caso clínico: Paciente femenino de 47 años con antecedentes
de: hipotiroidismo, NAC a repetición.
Cursa internación en sala general por NAC
cavitada, con requerimiento de decorticación pleuropulmonar que a las 72 hs
evoluciona con shock distributivo con FMO con requerimiento IOT y ARM.
Por mejoría evolutiva y ARM prolongado se
decide realizar traqueostomía y ventana pleuro pulmonar por fístula
broncopulmonar.
Se recibe laboratorio reumatológico, que
presenta ANCA-C positivo.
Inicia meprednisona y ciclofosfamida,
evolucionando con neutropenia que revierte con estimuladores de colonias.
Intercurre con deterioro del sensorio,
progresando a coma. Se solicita Tomografía encéfalo: lesiones hipodensas en
lóbulos parietales, cerebelosas periféricas cortico-subcorticales sugestivas de
PRESS e hidrocefalia no comunicante. Ante la urgencia se procede al drenaje de
LCR por vía transorbitaria. Se realiza también angioresonancia de encéfalo que
evidencia extensa área hiperintensa en T2 y FLAIR cortico-subcorticales a nivel
temporo parieto occipital bilateral en ambos hemisferios cerebelosos y vermis,
provocando obliteración del 4to ventrículo, causando hidrocefalia leve.
Se coloca drenaje ventricular externo y se
realizan medidas de neurointensivismo. Tomográfica control sin nuevas lesiones
e hidrocefalia, se realiza vacación de sedación con respuesta positiva sin foco
motor, ni sensitivo, respondiendo a órdenes simples. Se retira Derivación
ventricular externa
La paciente se desvincula de ARM y deriva a
centro de rehabilitación por miopatía del paciente crítico.
Discusión: La hidrocefalia no comunicante es poco
frecuente, su persistencia produce aumento de la presión intracraneal causando
hernias encefálicas.
La punción trans-orbital es un procedimiento
que se realiza en techo de la órbita con una aguja de punción lumbar, cuya
complicación a tener en cuenta es traspasar parte del lóbulo frontal, pero se
justifica el riesgo porque resuelve una situación que puede ser fatal.
Conclusión: Reportamos este procedimiento ya que es poco
frecuente realizarlo ante la presencia de hidrocefalia no comunicante como
mecanismo de rescate previo a la colocación de derivación ventricular externa,
pudiendo usarse en casos de emergencia
0232 Prevalencia de Ventilación
Mecánica prolongada en pacientes con TEC GRAVE
MD Bovetti
Galván(1), De San Martin, DM Miqueri(1),
De San Martin, LN Rodriguez(1), De San Martin, LM Ramirez(1), De San
Martin, VA Medina(1), De San Martin, AM Caliva(1), De San Martin, FS Flores
(1) Hospital Escuela Jose F. (2) De San Martin.
Fundamento: El Traumatismo Encefalo Craneano es una de
las principales causas de discapacidad y muerte en nuestro país. Si se analizan
los costos en términos de la gravedad de la lesión, los fallecidos y los
heridos graves representan el mayor gasto, explicado básicamente por la
relevancia de los costos humanos, la pérdida de productividad y los gastos en
salud consecuentes por la prolongada internacion de los mismos que conllevan a
devastadoras consecuencias,principalmente en las primeras cuatro décadas de la
vida.
Objetivo: Analizar la incidencia de ventilación
mecánica prolongada en pacientes internados en el Hospiral Escuela Jose F. de
San Martin que hayan sufrido traumatismo craneoencefálico grave del adulto
durante el periodo 2020-2021.
Metodología: Se realizó un estudio descriptivo longitudinal
no participativo en pacientes ingresados con traumatismo craneoencefálico grave
en el servicio de Terapia Intensiva del Hospital Escuela Jose F. de San Martin,
Corrientes, Argentina, desde el 1ro de enero de 2020 hasta 31 de diciembre de
2021. Se aplicaron métodos de estadística descriptiva.
Resultados: Se recolecto información de 90 pacientes
ingresados al servicio, de los cuales el 60% fueron menores de 45 años, 77,8%
(70) fueron de sexo masculino, con una taza de supervivencia del 58,9% (53), de
los cuales el 44,2% (23) requirió ventilación mecánica prolongada durante su
internación.
Conclusiones: El traumatismo craneoencefálico grave
predomina en pacientes menores de 45 años, del sexo masculino y procedencia urbana;
casi la mitad de los pacientes que ingresan al servicio de terapia intensiva
por haber sufrido esta condición, requieren de una internación prolongada con
requerimientos de ventilación mecánica invasiva para poder seguir viviendo, lo
que representa un costo elevado para la atención de los mismos. Todos los
fallecidos tuvieron alguna complicación durante su evolución.


0234 ACIDOSIS LACTICA
SECUNDARIO A INTOXICACION POR METFORMINA
P Zuleta Chambi(1),
A Bonilla(1), E Polo(1), J Rivadeneira(1)
(1) Hospital Del Trauma Dr Federico Abete.
Introducción: La acidosis láctica por metformina es rara
pero alcanza una mortalidad del 50% la incidencia es de 3 casos por cada
100.000 pacientes tratados por año, la intoxicación voluntaria es poco
habitual, los niveles de metformina en sangre no son determinados en los
resultados del paciente intoxicado mientras que el lactato en sangre y la
disfunción multiorganica se considera factores de riesgos de mortalidad, presentamos
el caso clínico de una paciente con intoxicación por metfomina con fin
autolitico que evoluciona con disfunción multiorganica y cuya resolución del
cuadro clínico fue la hemofiltracion continua.
Presentación del caso: Paciente femenina de 39 años de edad con
antecedentes de asma, obesidad, hipertensión arterial, diabetes mellitus tipo
II, hipotiroidismo, refiere ingesta de metformina 500mg total de 7 comprimidos
(3500 mg) con fin autolítico ingresa con Glasgow 15/15 lucida, posteriormente
evoluciona con caída de Glasgow 10/15 con episodios de excitación psicomotriz,
más acidosis metabólica, acidosis láctica, mala mecánica ventilatoria,
requiriendo de ventilación mecánica invasiva ingresa a unidad terapia intensiva
evoluciona con shock refractario y disfunción multiorganica ( renal,
hemodinámica, neurológica, metabólica, hepática) requerimiento de bicarbonato y
terapia de remplazo renal continua, intercurre con rabdomiolisis con buena
respuesta a cristaloides, con resolución de las disfunciones se llega a
extubacion programada con cambio de interface a ventilación no invasiva buena
evolución pasa a sala de menor complejidad
Discusión: Una estrategia controversial que no está toda
validada en acidosis láctica e inestabilidad hemodinámica independiente de la
etiología es el uso de bicarbonato de sodio, en esta medida es considerado como
tratamiento puente mientras se instaura el tratamiento etiológico
Conclusión: La acidosis láctica por metformina es poco
frecuente, diagnosticar el mecanismo y la causa de la acidosis láctica de
manera rápida favorecerá al tratamiento dirigido de forma temprana, la acidosis
láctica condicionada por metformina tiene mejor pronostico, respecto a la
inducida por choque séptico, la terapia de remplazo renal continua, deberá ser utilizada
como primer eslabón al tratamieto con la acidosis láctica por metformina.


0235 REPORTE DE CASO DE
PARACOCCIDIOIDOMICOSIS DISEMINADA
E Cautures(1), V
Torres(1), JI Ibarzabal(1), JC Pendino(1), FO Fiorilli(1), LR Bettini(1)
(1) Hospital Provincial Del Centenario.
Introducción: La paracoccidioidomicosis es una enfermedad
sistémica progresiva, producida por el hongo Paracoccidioides. Suele afectar
hombres latinoamericanos, por ser endémico de esta región. Su principal
localización es pulmonar, con lesiones secundarias en mucosas y piel, raramente
afecta el sistema nervioso central. La principal herramienta diagnóstica es la
visualización directa al microscopio. El tratamiento de elección se propone con
itraconazol y anfotericina B.
Caso clínico: Varón de 46 años, procedente de Paraguay.
Traído por cuadro progresivo de debilidad, pérdida de peso, alteraciones de la
conducta, afasia, y depresión del sensorio. Se realiza tomografía (TAC) de
cráneo que evidencia lesiones hipodensas con refuerzo en anillo (Figura 1), VIH
negativo, y punción lumbar con leve hiperproteinorraquia, 16 elementos/mm3.
Ingresa a unidad de cuidados críticos para monitoreo inicial estricto.
Se solicita TAC de tórax, que muestra
múltiples lesiones cavitadas bilaterales (Figura 2), ante estos hallazgos los
servicios interconsultores intervinientes sugieren iniciar tratamiento
antituberculoso empírico. Se realiza lavado broncoalveolar (BAL) previo a
modificar conducta terapéutica donde se obtiene exámen directo negativo para
BAAR, por lo que se solicita la búsqueda específica de Paracoccidioides spp.
con resultado positivo.
Se inicia tratamiento con anfotericina B
liposomal, evoluciona estable, continuando tratamiento en sala general, en plan
de rehabilitación y recuperación nutricional.
Discusión: La secuencia de hallazgos clínicos e
imagenológicos obligó a descartar la tuberculosis como etiología, por ser una
de las enfermedades endémicas más frecuentes en nuestro medio.
El diagnóstico se obtuvo mediante observación
directa de Paracoccidioides en la muestra de BAL. No se disponía al momento de
pruebas serológicas que muestran gran sensibilidad y especificidad (>90%).
Para las formas invasivas de esta enfermedad
se recomienda anfotericina para luego rotar a itraconazol. Ante ciertas
contraindicaciones, trimetoprima/sulfametoxazol puede utilizarse. Además,
existe evidencia de que pacientes con gran compromiso inflamatorio, o que se
presenten con insuficiencia respiratoria, se benefician del uso de corticoesteroides.
Conclusión: Consideramos pertinente la comunicación de
este caso ya que la fuerte sospecha de una micosis relacionada al foco
epidemiológico llevó a tomar conductas diagnóstico terapéuticas que permitieron
establecer el diagnóstico etiológico con relativa facilidad y rapidez, e
iniciar el tratamiento específico de manera oportuna.


0237 SINDROME CATATONICO: UN
DESAFIO PARA LAS UNIDADES CRITICAS. A PROPOSITO DE UN CASO
I Petel(1), M Steinberg(1),
M Cozzi(1), MA Barrientos(1), D Vera(1)
(1) Naval.
Introducción: La catatonia es un síndrome
neuropsiquiátrico, de baja prevalencia, caracterizado por anormalidades
motoras, asociadas a alteraciones de la conciencia que se manifiestan como
eventos de delirio hiperactivo.
El delirio hiperactivo constituye una
patología frecuente entre los pacientes críticos. Se asocia a destete
prolongado, incremento en los días internación y mayor riesgo de complicaciones
asociadas a los cuidados de la salud, lo que conlleva aumento de la
morbimortalidad. Las causas delirio son multifactoriales, y el manejo
constituye un desafío para los intensivistas.
Presentación del caso: Varón de 59 años hipertenso sin antecedentes
neuropsiquiátricos, que ingresa a Terapia Intensiva por destete dificultoso
debido a excitación psicomotriz, en el contexto de post PCR intraoperatorio.
En Terapia Intensiva presenta episodios de
excitación psicomotriz asociados a cuadros hiperadrenérgicos con múltiples
manifestaciones neurológicas asociadas, lo que dificulta el destete de la
asistencia ventilatoria mecánica, requiriendo traqueostomía. Se aplican
diferentes esquemas de tratamiento con psicofármacos, sin respuesta favorable.
Se llega al diagnóstico de síndrome catatónico. Se decide iniciar Terapia
Electroconvulsiva. Se obtienen buenos resultados, el paciente es dado de alta
al domicilio.
Discusión: Exponemos un caso de síndrome catatónico post
PCR intraoperatorio, manifestado por excitación psicomotriz de difícil manejo,
donde el manejo habitual, no tuvo respuesta satisfactoria. Ante la sospecha de
síndrome catatónico, se utilizó la Escala de Bush Francis, obteniéndose un alto
puntaje, llegando al diagnostico de Síndrome Catatónico. Se propuso la
realización de Terapia Electroconvulsiva, se obtuvieron buenos resultados a
corto plazo. Valoraremos el síndrome catatónico como posible causa de delirio
en los pacientes críticos, y comentaremos el uso de la Terapia
Electroconvulsiva como tratamiento especifico.
Conclusión: La catatonia es una entidad de baja
prevalencia, de la que hay pocos reportes de casos en la bibliografía. Como
parte del tratamiento se describe la Terapia Electroconvulsiva, siendo la misma
controversial y marcada desde hace muchos años por los enfoques coercitivos que
la relacionan con la visión ética y humana de la atención medica.
Creemos que la descripción de este caso
clínico nos puede ayudar a ampliar el abanico de causas de delirio y trastornos
neuropsiquiátricos que se pueden manifestar en los pacientes críticos.
0239 INSUFICIENCIA TRICUSPÍDEA
TRAUMÁTICA
A Ramirez Juncos(1),
PB Pahnke(1)
(1) Hospital Municipal De Urgencias.
Introducción: La insuficiencia tricuspídea traumática (ITT)
es una lesión singular asociada al trauma de tórax contuso (TTC), con o sin
contusión miocárdica. Su manifestación clínica oscila desde silente hasta shock
cardiogénico, dependiendo de la magnitud del daño estructural. Frecuentemente
pasan desapercibidas inicialmente y, desafortunadamente, se diagnostican post
deterioro de la función VD.
Presentación del caso: Masculino, 33 años ingresa al SHock Room con
trauma facial y TTC, ISS:20, por colisión moto vs auto. SCG 15/15, TA: 133/92
mmHg, FC: 78 lpm, FR: 20 rpm, Sat: 89%; ECG FA mod RV; Estigmas torácicos; ondas
prominentes en vena yugular izquierda, soplo holosistólico 1/6 paraesternal
izquierdo. TAC: fractura maxilar inferior (cuerpo y ramas, con desprendimiento
y luxación de cóndilos); fractura condral segunda costilla paraesternal;
contusión y laceración pulmonar bilateral. Troponinas I 2174/2260/1227/829/593
ProBNP 796/1043/1595. ETT insuficiencia tricuspídea con mínimo aumento del
diámetro del anillo tricuspídeo. Cardiorresonancia insuficiencia valvular
mitral leve y tricuspídea moderada, función sistólica, tamaño, contractilidad y
perfusión tisular biventricular conservados. ETE rotura cuerda tendinosa de
primer orden valva posterolateral, insuficiencia tricuspídea moderada, con
cavidades y función sistólicas derechas normales. Cardioversión farmacológica,
osteosíntesis maxilar. Interconsulta a centro con CCV. Alta 6°día.
Discusión: En politraumatizados, la ITT puede ser no
detectada inicalmente. El mecanismo de ruptura del aparato valvular o ”blowout”
se basa en que la abrupta aceleración-desaceleración o compresión-descompresión
anteroposterior del tórax al final de la diástole, genera un aumento de las
presiones cardíacas derechas, con la consiguiente avulsión del aparato
valvular. El alto índice de sospecha diagnóstica se basa en el mecanismo
lesional, signos clínicos, cambios electrocardiográficos, biomarcadores
elevados; y se confirma con imágenes multimodales cardiacas. La corrección
quirúrgica no está establecida. Los signos de insuficiencia cardíaca derecha
indican la reparación temprana, preservando la función ventricular derecha. Las
imágenes dinámicas determinan el momento quirúrgico en casos asintomáticos.
Conclusión: La ITT es infrecuente y se manifiesta con una
amplia gama de presentaciones clínicas en el contexto de TTC. Ante signos de
sobrecarga derecha, arritmias o bloqueos nuevos, con curva enzimática
ascendente, se debe descartar contusión miocárdica y lesión tricuspídea
subyacente.

C Parellada(1), GV
Claro(1), KE Jakobsen(1), MJ Arias(1), J Fain(1), S Pellegrini(1), M
Truszkowski(1)
(1) Hospital De Pediatría “prof. J. P.
Garrahan”.
Introducción: Se define como traqueobroncomalacia (TBM) a la
patología determinada por un anormal soporte de la tráquea y los bronquios.
Esta característica puede conducir al colapso de la vía aérea. La incidencia
reportada varía entre 1:1500 a 1:2500 y puede ser congénita o adquirida, aunque
está última es poco frecuente. La presentación clínica es variable y depende de
la severidad de la malacia, pudiendo encontrar casos leves hasta severos con
riesgo de vida. El diagnóstico requiere una alta sospecha clínica y
confirmación endoscópica. Presentaremos tres casos severos de dicha patología,
uno de los cuales requirió colocación de exoesqueleto.
Presentación de los casos: - Caso 1: Lactante de
3 meses de edad, de sexo masculino, con diagnóstico de acondrodisplasia,
hospitalizado desde su nacimiento requiriendo soporte ventilatorio mecánico
(SMV) por cianosis y dificultad respiratoria. Se diagnosticó TBM por
traqueografía realizándose reparación quirúrgica a los 4 meses de edad.
Permaneció en el post operatorio con SMV por 90 días con altos requerimientos
de sedación y titulación de PEEP los primeros días. Presentó dificultades para
destetarse de la presión positiva por lo que requirió la realización de
traqueostomía, permaneciendo con presión positiva de dos niveles en las vías
respiratorias (BiPAP).
- Caso 2: Lactante de 2 meses de edad, de sexo
femenino, con síndrome genético no caracterizado, requiere SMV desde su
nacimiento, es diagnosticada con TBM severa y se realiza traqueostomía.
Requirió varias cirugías correctivas sin éxito, por lo que se decidió la
reconstrucción 3D de la vía aérea logrando, luego de 3 meses, destetarse de la
presión positiva.
- Caso 3: Lactante de 2 meses de edad, de sexo
masculino, con diagnóstico de síndrome de Down y requerimiento de SMV desde su
nacimiento, es derivado para realización de traqueografía. Se diagnostica TBM,
y se realiza traqueoplastía a los 3 meses de edad logrando destetarse de la
presión positiva luego de 2 meses.
Discusión: El manejo de la TBM severa es complejo y los
pacientes son heterogéneos. Por lo tanto, el tratamiento debe adaptarse
cuidadosamente a cada paciente. A menudo se necesita un equipo
multidisciplinario de cirujanos otorrinolaringólogos, intensivistas, cardiólogos
y cirujanos cardiovasculares.


G Rolandelli(1), I
Petel(1), F Larocca(1), E Barone(1), D Vera(1)
(1) Naval.
Introducción: El estridor post extubación es una condición
potencialmente fatal de no ser tratada a tiempo; se asocia a edema o disfunción
de cuerdas vocales, secreciones, traqueomalacia u obstrucción. Describiremos el
caso de un episodio de estridor tardío postextubación secundario a obstrucción
por pseudomembrana traqueal fibrinosa.
Presentación del caso: Mujer cursando gesta de 37 semanas que
ingresa por preeclampsia y neumonía por SARS COV2, requiere cesárea de
urgencia. A las 24 horas requiere de intubación orotraqueal y ventilación
mecánica invasiva por distress respiratorio.
Al noveno día se extuba, sin estridor ni
broncoespamo, con disfonía, tos efectiva y sensación intermitente de cuerpo
extraño a nivel torácico.
Al tercer día presenta marcada disfonía,
estridor, con incremento del trabajo respiratorio y sensación de cuerpo
extraño. Se decide realizar fibrobroncoscopía flexible.
Se observa a nivel de tercio superior de
tráquea una membrana blanco grisácea fibrinosa adherida a pared traqueal que
generaba efecto de doble luz, permitiendo el pasaje de aire y generando colapso
dinámico, con oclusión parcial en espiración.
Se procede a extracción de la misma con
fibrobroncospía. Revierte los síntomas posterior a la extracción, presenta
franca mejoría de la mecánica ventilatoria y ausencia de estridor.
Fue dada de alta. Se realizo al mes
fibrobroncoscopía de control, sin evidencia de lesiones.
Discusión: El proceso de extubación es un paso critico
en el manejo de los pacientes de Terapia Intensiva, el estridor y la
obstrucción de la vía aérea son complicaciones, afortunadamente poco
frecuentes, pero que de no ser tratadas a tiempo ponen en riesgo la vida del
paciente. Asociado la presencia de pseudomembranas puede pasar inadvertida,
obstruyendo la luz traqueal.
Por esto creemos que es pertinente revisar el
uso de la fibroscopía como piedra angular del diagnostico de las complicaciones
en el proceso de extubación de los pacientes críticos.
Conclusión: La estridor asociado a la pseudomembrana
traqueal ha sido descripto con frecuencia en la pandemia SARS COV2 debida al
elevado número de pacientes que requirieron ventilación mecánica, con periodos
prolongados de asistencia ventilatoria mecánica. Los síntomas descriptos por
nuestra paciente, coinciden con lo descripto en la bibliografía. En nuestro
caso la realización de la fibroscopía fue clave para la resolución
satisfactoria del cuadro.
D Vasquez(10), R
Giannoni(1), A Salvatierra(2), K Cisneros(3), D Lafosse, F Escobar(4), M
Montenegro(5), P Juárez, L Visani(6), V Mandich(7), E Barrozo(8), M
Kirschbaum(9), G Plotnikow(10), MF Valenti(11), MC Canseco(12), I Romero(13), P
Macharé(14), A Marquez(15), E Rodriguez(16), C Palacio(17), L Rapela(18), J
Amillategui Scenna(19), R Nuñez(20),
Torres
(1) Hospital Regional Ramón Carrillo. (2)
Hospital Del Este “Eva Perón”. (3) Sanatorio Antártida. (4) Fundación Valle Del
Lili. (5) Hospital Materno Infantil Ramón Sardá. (6) Hospital Cuenca Alta
Néstor Kirchner. (7) Hospital Santojanni. (8) Maternidad Provincial Teresita
Baigorria. (9) Sanatorio Finochietto. (10) Sanatorio Anchorena. (11) Sociedad
Argentina De Terapia Intensiva. (12) Instituto De Maternidad Y Ginecología
Nuestra Señora De Las Mercedes. (13) Sanatorio Güemes. (14) Hospital Mi Pueblo.
(15) Hospital Municipal De Morón. (16) Hospital Simplemente Evita. (17)
Sanatorio Itoiz. (18) Hospital Municipal Del Carmen. (19) Hospital Provincial
Del Centenario. (20) Hospital Mariano Y Luciano De La Vega. (21) Sanatorio
Anchorena San Martín. (22) Hospital Interzonal General De Agudos Gral. San
Martín.
Introducción: La información disponible sobre pacientes
obstétricas con insuficiencia respiratoria aguda que requieren ingreso a UTI
proviene de series de casos de hasta 71 pacientes.
Objetivo: Analizar características generales y
evolución de pacientes embarazadas/puérperas con COVID-19 que requirieron
ingreso a 21 UTIs de Argentina y Colombia requiriendo soporte ventilatorio
avanzado (20/3/21-31/12/21).
Materiales y métodos: Estudio de cohorte prospectivo multicéntrico.
Resultados: Ingresaron 91 pacientes. En la tabla 1 se
muestran sus características generales, evolución y diferencias entre
sobrevivientes (SV) y No sobrevivientes (NoSV). Al ingreso a UTI 36(39.5%)
requerían cánula nasal de alto flujo (CNAF), 28(31%) máscara reservorio (MR),
20(22%) ventilación mecánica invasiva (VMI), 5(5.5%) cánula de bajo flujo
(CNBF) y 2(2%) ventilación-No-invasiva(VNI). Soporte ventilatorio al ingreso
para SV vs. NoSV: [CNAF:28(37.3%)vs.8(50%); MR:23(30.6%)vs.5(31.5%);
VMI:17(22.6%)vs.3(18.75%); CNBF:5(6.7%)vs.0; VNI:2(2.7%)vs.0; p0.71].
24/36(66.6%) de las que ingresaron con CNAF y 21/28(75 %) de las que ingresaron
con MR requirieron VMI(p0.48).
Parámetros respiratorios durante la 1°semana
y diferencias entre SV y NoSV: Figura-1. Variables significativamente
diferentes entre SV/NoSV: presión plateau (PP) al 2° y 7°día y driving pressure
(DP) al 7°día (p<0.05). PaO2/FiO2 durante la primera semana fue
significativamente diferente al día 0 vs. 2° y 7°día (p0.000). 20 pacientes
requirieron CNAF como máximo soporte ventilatorio vs. 69 que requirieron VMI;
siendo las diferencias significativas entre estos dos grupos: IMC 27.2±3.5 vs.
30.2±6 (p0.010), APACHEII 7[5.5-12.5] vs. 14[9-19] (p0.001), SOFA24 2.5[2-4]
vs. 5[4-7] (p0.000) y alta con embarazo en curso 8/14(57.1) vs 4/54(7.4)
(p0.0002). La mortalidad de las pacientes que requirieron VMI fue de 23.2%(16).
Conclusiones: La mayoría de las pacientes pertenecían al
sector público de salud y no estaban vacunadas. Si bien la mayoría no
presentaba comorbilidades, la presencia de alguna comorbilidad fue más
frecuente en el grupo de NoSV. Cuarenta por ciento presentaba obesidad, siendo
la obesidad clase II fue más frecuente que la clase I entre NoSV. El uso de
CNAF vs. MR no evitó la necesidad de VMI. La mortalidad de las pacientes bajo
VMI fue significativamente inferior a la descripta para la población general
COVID-19. Los parámetros respiratorios que evidenciaron diferencias entre SV y
NoSV fueron PP Y DP.


0245 CRANIECTOMÍA DESCOMPRESIVA
PRIMARIA EN TRAUMATISMO CRANEOENCEFÁLICO GRAVE
F Garavelli(1), M
Re(1), N Rocchetti(1), F Di Paolo(1), M Latimori(1), M Ramirez Colombres(1), C
Maenza(1), S Gattino(1), C Settecase(1), D Bagilet(1), J Meoli(1)
(1) Hospital Eva Peron.
Introducción: La craniectomía descompresiva (CD) puede ser
primaria (CDP) o secundaria (CDS). Factores clínicos pronósticos pueden cobrar
relevancia para evaluar la utilidad de realizar CDP en pacientes con trauma
craneoencefálico grave (TCEG).
Objetivos: Primario: Analizar factores pronósticos que
influyan en la morbimortalidad de pacientes con TCEG y CDP. Secundario:
Describir características socio-demográficas, clínico-analíticas,
imagenológicas, evolución y morbimortalidad.
Materiales y métodos: Estudio analítico, descriptivo, observacional,
de cohortes, retrospectivas. Incluyó mayores de 16 años, internados
consecutivamente por TCEG con requerimiento de CDP, en la UCI del Hospital
Escuela Eva Perón, entre el 01/01/2019 y el 01/06/2022. Análisis estadístico:
variables cualitativas se expresaron como porcentajes, cuantitativas como
medianas y rango intercuartilo (Q3-Q1). Análisis de regresión logística binaria
univariado y multivariado para expresar la fuerza de la asociación entre
mortalidad y factores pronósticos. Se asumió significativa p≤0,05, se calculó
Odds Ratio (OD) e intervalo de confianza 95% (IC). El trabajo fue aprobado por
el Comité de Docencia e Investigación del hospital.
Resultados: 41 sujetos requirieron CDP, 85,4% hombres,
mediana de edad 34 años (48-21), estancia hospitalaria de 11 días (23-5). Las
CDP fronto-parieto-temporal y fronto-temporal (24,4%) fueron más frecuentes. Se
realizó la división en dos grupos: GRUPO 1= fallecidos 11 (26,8%) vs. GRUPO 2=
sobrevivientes 30 (73,2%). El análisis de regresión logística bivariante
univariado encontró diferencias significativas en: Escore de Glasgow (Grupo 1=5
(3-9) vs. Grupo 2=8 (7-9) p= ,004); APACHE II (Grupo 1=21 (6-42) vs. Grupo 2=11
(3-24) p= ,007); SAPS II (Grupo 1=56 (14-70) vs. Grupo 2=37 (7-62) p= ,030);
SOFA (Grupo 1=9 (4-27) vs. Grupo 2=4 (2-12) p= ,016); Retrascore (Grupo 1=5,72
(0-11) vs. Grupo 2=3,11 (0-7) p= ,020); Escala Marshall (Grupo 1=4 (2-5) vs.
Grupo 2=2 (1-5) p= ,021); anisocoria (Grupo 1=8 vs. Grupo 2=8 p= ,044). En el
análisis de regresión logística binaria multivariado todas las variables
perdieron significancia estadística. Sin embargo, al quitar las variables SOFA,
Glasgow, SAPS II y retrascore, por colindancia de variables, manteniendo
anisocoria y APACHE II, estas continuaron presentando significancia
estadística.
Conclusión: La mortalidad fue del 26%. En una población
con TCEG con requerimiento de CDP en UCI, anisocoria y APACHE II se comportaron
como predictores de mortalidad en UCI.
0246 covid multisistemico del
adulto
M Gardeazabal Rospilloso(1),
MR Gardeazabal Rospilloso(1), J Vilca(1), I Parodi(1), M Cordoba(1), A
Cucci(1), F Morales(1), AL Piñas(1), L Tumino(1), C Loudet(1), A Toro(1)
(1) Higa San Martin.
Introducción: El síndrome inflamatorio sistémico del adulto
(SIM-A) es una complicación de baja incidencia en adultos infectados por
SARS-CoV-2. Los pacientes afectados suelen ser jóvenes o de mediana edad y se
caracterizan por una respuesta inflamatoria desregulada.
Presentación de caso: Paciente de23 años femenina sin antecedentes
personales de relevancia, cursando puerperio inmediato.Es derivada de otro
nosocomio por sospecha de purpura trombocitopénica trombótica (PTT) para
realizar plasmaféresis por plaquetopenia y anemia asociada a esquitositos en
frotis periférico.
Ingresa a UTI estable, afebril, buena
mecánica ventilatoria, sin signos de fallo de bomba. Evoluciona en 36 hrs con
insuficiencia respiratoria aguda con requerimiento de ARM. Evoluciona con SDRA
con requerimiento de prono ;en tomografía computada se evidencia opacidades en
vidrio esmerilado, consolidaciones bilaterales a predominio derecho; protocolo
para TEP negativo. Se obtiene resultado antígeno para SARS-CoV-2 positivo. Se
realiza ecocardiograma con FEY conservada, dilatación de cavidades derechas, hipertensión
pulmonar severa, insuficiencia tricúspidea moderada y derrame pericárdico leve.
Evoluciona con requerimiento de inotrópicos y falla renal. Presenta además
ferritina elevada (2130) eritrosedimentación 24, proteína C reactiva de 159.
Considerándose el cuadro cardiológico sumado a plaquetopenia en contexto de
SARS-CoV-2 positivo cumpliendo criterios para SIM-A se inicia tratamiento con
gammaglobulina a razón de 2gr/ kilo peso.
La paciente presenta evolución favorable, con
mejoría de oxigenación, de función renal y estabilidad hemodinámica. Al cuarto
día se repite ecocardiograma con patrón normal, se decide extubación. Se va de
alta de terapia intensiva a los 10 días de su ingreso.
Discusión: El SIM-A es una entidad de difícil
diagnóstico por la inespecificidad del cuadro, con escasos reportes de casos en
la literatura actual. Resulta un desafío para enfocar diagnósticos
diferenciales y decidir estrategias terapéuticas que aún se encuentran en
discusión, con mucha información extrapolada de población pediátrica.
Conclusión: El Síndrome Inflamatorio multisistémico es
una entidad sin un cuadro clínico especifico, que se plantea ante la sospecha
diagnóstica frente a múltiples síndromes en el contexto de infección actual o
precedente por SARS-CoV-2.Al ser una entidad poco incidente en adultos se
cuenta con muy poca información no solo para el diagnóstico sino además para
los posibles tratamientos.
0247 SHOCK SÉPTICO POR SÍNDROME
DE LOEFFLER. REPORTE DE UN CASO
G Gomez(1), ML
Campassi(1), F Repetto(1), D Banegas(1), M Cuitiño(1), B Tiseyra(1), I
Ramirez(1), L Flores Trusso(1), C Fauez(1)
(1) Clinica La Pequeña Familia.
Introducción: El Strongyloides stercoralis es un nematodo
intestinal, endémico en áreas rurales, tropicales y subtropicales, y se asocia
con un amplio espectro de manifestaciones y síndromes clínicos. En Argentina,
estudios descriptivos han informado prevalencias de parasitosis mayores al 80%
en algunas localidades del norte y sur del país, mientras que en la zona
central se registran porcentajes cercanos a 45%.
Caso Clínico: Paciente de 56 años oriundo de Chaco con
antecedentes de tabaquismo, hiperuricemia, histoplasmosis de reciente
diagnóstico. MH: omeprazol 20 mg, itraconazol 400 mg y meprednisona 40 mg.
Es derivado por cuadro de 7 días de evolución
caracterizado por dolor abdominal asociado a náuseas, astenia y adinamia.
Ingresa vigil, con signos de hipoperfusión en insuficiencia ventilatoria, por
lo que requiere IOT/ARM, reanimación con fluidos y vasopresores en dosis alta.
Se toman hemocultivos x 2, urocultivo y AT e inicia tratamiento empírico con
vancomicina + meropenem. Se recibe resultado de AT positivo para Strongyloides
stercolaris, por lo que se agrega ivermectina. Se re-interpreta el cuadro como
shock séptico con FMO 2rio a síndrome de Loeffler. Evoluciona con PCR y se
realizan maniobras de RCP avanzada, sin éxito.
Comentarios: La presentación sistémica de esta enfermedad
se observa más frecuentemente en individuos inmunocomprometidos, siendo el
pulmón, piel, mucosas, médula ósea y SNC los principales sistemas de choque. Es
rara su presentación sistémica en individuos inmunocompetentes.
Conclusión: Reportamos este caso dado que es una
patología poco frecuente pero que debe ser sospechada en todas aquellas
personas con epidemiología compatible, independientemente de su estado
inmunológico basal. El desafío real es realizar el screening antes y durante
los tratamientos con inmunosupresores. Además el reconocimiento temprano y el
tratamiento específico evitan una evolución fatal de estas infecciones, pero el
diagnóstico es dificultoso porque las manifestaciones clínicas son
inespecíficas.

0248 HEMORRAGIA SUBARACNOIDEA
COMPLICADA CON SINDORME DEL CORAZON ROTO
P Spina(1), P
Amancay(1), G Gimenez(1), L Iglesias(1), A Peñaloza(1), S Enzo(1), G
Scuaglia(1)
(1) Sanatorio Del Salvador.
El síndrome de Takosubo representa una
disfunción ventricular izquierda, es causado por estrés emocional, físico
intenso 0 injurias cerebrales severas. Su incidencia en las hemorragias
subaracnoideas es de 26% .
Se presenta paciente femenina de 55 años con
antecedentes de hipotiroidismo que consulta por depresión del sensorio de una
hora de evolución aproximadamente previo a dificultad respiratoria y mal estar
general. A su ingreso somnolienta, Glasgow 14/15 sin foco motor con cefalea
retro ocular frontal occipital intensa asociado a nauseas con episodios de
vómitos biliosos durante la mañana.
Se realizó una TAC de cerebro que informa
leve hemorragia frontal bilateral y edema cerebral difuso, se avisa a servicio
de neuro cirugía quien indico Angio RMN que muestra aneurisma de la arteria
comunicante posterior izquierda de 4.5mm.
Se procedió a angiografía y clipado
aneurismático sin complicaciones.
A las 24 horas evoluciona con hemiparesia
braquioclural derecha 3/5 compatible con vaso espasmo sintomatico, se realiza
nueva imagen cerebral sin cambios respecto a la previa. Se inicia NAD para
mantener TAM.
El día siguiente intercurre con depresión del
sensorio, convulsiones y taquicardia ventricular sostenida con posterior PC,
sale del mismo en shock cardiogenico con requerimiento de inotrópicos y
vasopresores a altas dosis.
Ecocardiograma doppler informo deterioro
severo de la función sistólica, FEY menor al 15% con hipocinesia global,
cinecoronariografia descarta enfermedad coronaria; y un venticulograma mostro
trastornos de la motilidad compatible con miocardiopatia por estres.
Evoluciona con shock cardiogenico refractario
y síndrome febril posteriormente falla multiorganica y óbito
La miocardiopatía de takosubo es un síndrome
agudo reversible que aumenta la mortalidad en HSA. Para el diagnóstico se
utilizan examen de laboratorio, electrofisiológicos, de imágenes, circulatorios
y los criterios diagnósticos inter TAK para diferenciar el SST del SCA.
El shock cardiogénico no es infrecuente en
asociación a STK y se asocia a un peor pronóstico a corto y largo plazo, en
contexto de HSA. El tratamiento es individualizado, y el empleo de levosimendán
fue más efectivo que el de los inotrópicos adrenérgicos. Se justifica el
seguimiento sistemático y regular de electrocardiograma y ecocardiograma para
la detección temprana.
0249 PACIENTE JOVEN CON
MICROAGIOPATIA TROMBÓTICA INDUCIDA POR SEPSIS
F Garavelli(1), M
Re(1), N Rocchetti(1), F Di Paolo(1), M Latimori(1), M Ramirez Colombres(1), C
Maenza(1), S Gattino(1), C Settecase(1), D Bagilet(1)
(1) Hospital Eva Peron.
Introduccion: La microangiopatía trombótica (MAT) es un
trastorno que causa trombosis microvascular con trombocitopenia y anemia
hemolítica, y puede ser inducida por sepsis (sMAT).
Caso clínico: Mujer de 41 años, antecedentes: VIH en
tratamiento, neurotoxoplasmosis, G5P3A2, tabaquista, cocainómana. Ingresa por
dolor en hemiabdomen inferior de 5 días de evolución, ginecorragia, fiebre,
convulsión e hipotensión. Examen físico: TAM 50mmHg; FC 100LM; FR 24CM, Tº
38ºc; GCS 13/15; PIRS, abdomen blando, distendido, doloroso, sin defensa ni
descompresión; resto sin particularidades. Requirió inotrópicos y AVM. Laboratorio:
Hb 7,3 mg/dl; leucocitos 11400 mg/dl; PCR 23 mg/dl; PCT 31,07; plaquetas
8000mm3; glucemia 104; uremia 279 mg/dl; creatininemia 6,3 mg/dl; albuminemia
2,4; natremia 132 mEq/L; kalemia 5,4 mEq/L; calcemia 7,2 mEq/L; fosfatemia 4,6
mEq/L; magnesemia 2,2 mEq/L; TGO 24; TGP 15; FAL 134; GGT 13, BT 2,2; BD 2,10;
LDH 1325; KPTT 25; TP11; Fibrinógeno 287 mg/dl; Dimero D 10,7; COOMBS,VDRL,
VHB, VHC negativos; Ph 7,43, PCO2 28, PO2 109, HCO3 18 mEq/L , EB -5,5, SatO2
98%. Factor reumatoideo negativo; FAN, ENA, C3, C4, ANCA C y P negativos;
proteinograma por electroforesis normal. Sub Beta HCG positivo (472UI);
haptoglobina < 10. Frotis: anisocitosis, poiquilocitosis, esquistocitos:
2/campo; plaquetas 6500/ml. LCR: glucosa 1,15 mg/dl; proteínas 2,7 gr/l, leucocitos
2898 mm3 (PMN 77%), Lactato 5,4mmol/L. Ecografía transvaginal: contenido en
cavidad uterina con burbujas aéreas. TAC cráneo: sin lesiones agudas. Escores
predictivos para ADAM-13 (Fruch y PLASMIC) de alto riego. Inicia
ampicilina/ceftriaxona/aciclovir; se transfundieron hemoderivados; realizó
plasmaféresis (5 sesiones), soporte dialítico e histerectomía. Urocultivo: E.
Coli; LCR, hemocultivos, útero y liquido ascítico negativos. Ajusta tratamiento
a ceftriaxona/clindamicina. Presentó buena evolución.
Discusión: La PTT primaria es causada por anticuerpos
contra ADAMTS13. En sepsis, citoquinas y elastasas de granulocitos clivan
ADAMTS13 y depletan sus niveles, provocando anemia hemolítica microangiopática
con trombocitopenia. Es frecuente el compromiso renal, pulmonar y del sistema
nervioso central. Ante la presencia de sMAT, la plasmaféresis puede ayudar a
remover los factores responsables del déficit de ADAMTS13, si bien su uso es
discutido.
Conclusión: Frente a un rápido descenso de hemoglobina y
plaquetas en contexto de sepsis debe sospecharse Smat. La plasmaféresis mejora
el pronóstico, aunque su eficacia no está establecida.
0250 Injuria pulmonar inducida
por Paraquat
VS Iglesias(1), S
Iturri(1), F Villarejo(1), P Damian(2),
Posadas, R Romina(4), P Jose(5), R Vitello(6)
(1) Nac. Prof.a. Posadas. (2) Nac.prof A.
(3) Posadas. (4) Nac. Prof.a.posadas.
(5) Nac. Prof. A. Posadas. (6) Nac. Prof. Posadas.
Introducción: El paraquat (PQ), herbicida difundido en
agricultura, según la OMS moderadamente peligroso.
Argentina no tiene datos epidemiológicos
exactos sobre la incidencia de intoxicación por PQ, se estima es menor al 2%.
Presentación: Productor rural, 56 años. Ingresa 48 hs tras
ingesta intencional de PQ (20 ml). Presenta odinofagia, sialorrea, vómitos,
úlceras mucosas. Laboratorio con leucocitosis y falla renal. Sin compromiso
clínico ni radiológico respiratorio. Prueba en orina confirma intoxicación por
PQ. Inicia tratamiento inmunosupresor con pulsos de ciclofosfamida y metilprednisolona.
A los 9 días: leve disnea e hipoxemia requiriendo oxigenoterapia de bajo flujo.
Tomografía (TC) de tórax: vidrio esmerilado en ambos campos pulmonares. Pasados
10 días inicia oxigenoterapia con cánula nasal de alto flujo (OCAF) por descenso
de oxigenación (tabla 1) con periodos en prono vigil con parcial mejoría. Dia
N°25 agrava insuficiencia respiratoria (IR) requiriendo ventilación mecánica
invasiva (VMI). Cumple dos ciclos de decúbito prono de 60 y 24 hs falleciendo a
30 días de ingesta por hipoxemia refractaria.
TC post-mortem ( anuencia familiar) muestra
neumotórax izquierdo, consolidación, broncograma, vidrio esmerilado, enfisema
subcutáneo y neumomediastino.
Tabla 1

Discusión: El PQ tiene afinidad por los neumocitos
generando especies reactivas de oxígeno y consecuentemente peroxidación de
lípidos, los radicales libres producen un comportamiento similar al SDRA
conduciendo a fibrosis pulmonar irreversible siendo la principal causa de
muerte según estudios epidemiológicos.
La IR generada y necesidad de oxígeno
suplementario lleva a formación de radicales libres que empeoran la respuesta
inflamatoria y situación clínica, coincidimos en buscar objetivos de saturación
periférica de oxígeno entre 88 y 90% limitando altas fracciones inspiradas.
Conclusión: Mencionado el similar comportamiento al SDRA
e inevitable progresión a fibrosis, la IR generada por PQ nos presenta un
desafío. Se implementó aquí OCAF, utilizada con éxito en la pandemia Covid-19
como alternativa ante VMI por los riesgos que conlleva, habida cuenta estos
pacientes deben ser considerados inmunodeprimidos tras recibir el esquema
terapéutico inicial. Por ello se plantea extender un método de sostén no
invasivo según la tolerancia del paciente lo permita.

D Vasquez(24), R
Giannoni(1), A Salvatierra(2), K Cisneros(3), D Lafosse(4), F Escobar(5), M
Montenegro(6), P Juárez(7), L Visani(8), V Mandich(9), E Barrozo(10), M
Kirschbaum(11), A Das Neves(12), MF Valenti(13), MC Canseco(14), I Romero(15),
P Macharé(16), A Marquez(17), E Rodriguez(18), C Palacio(19), L
Rapela(20), Amillategui S
(1) Hospital Regional Ramón Carrillo. (2)
Hospital Del Este “eva Perón”. (3) Sanatorio Antártida. (4) Hospital Materno
Infantil Dr. F Escardó. (5) Fundación Valle Del Lili. (6) Hospital Materno
Infantil Ramón Sardá. (7) Hospital De La Madre Y El Niño. (8) Hospital Cuenca
Alta Néstor Kirchner. (9) Hospital Santojanni. (10) Maternidad Provincial
Teresita Baigorria. (11) Sanatorio Finochietto. (12) Hospital Interzonal
General De Agudos Gral. San Martín. (13) Sociedad Argentina De Terapia
Intensiva. (14) Instituto De Maternidad Y Ginecología Nuestra Señora De Las
Mercedes. (15) Sanatorio Güemes. (16) Hospital Mi Pueblo. (17) Hospital
Municipal De Morón. (18) Hospital Simplemente Evita. (19) Sanatorio Itoiz. (20)
Hospital Municipal Del Carmen. (21) Hospital Provincial Del Centenario. (22)
Hospital Mariano Y Luciano De La Vega. (23) Sanatorio Anchorena San Martín.
(24) Sanatorio Anchorena.
Objetivo: Analizar las características obstétricas y
evolución fetal-neonatal en pacientes embarazadas/puérperas que ingresaron a 21
UTIs de Argentina y Colombia por COVID-19 requiriendo soporte ventilatorio
avanzado (20/3/21-31/12/21).
Materiales y métodos: Estudio de cohorte prospectivo multicéntrico.
Resultados: Ingresaron 91 pacientes: 28(31%) postparto
(finalización del embarazo (FE) a las 34±2.7 semanas) y 63(69%) anteparto con
una EG de 29.2±4.9 semanas y FE en UTI a las 31±4.4 semanas (EG al momento del
parto en el grupo admisión postparto vs. anteparto= p0.002). En el 60.5%(43/71)
la causa de FE fue materna, en 29.5%(21/71) materno-fetal y en 9.9%(7/71)
fetal. De las 63 pacientes admitidas anteparto, 43(68.3%) requirieron FE
durante la internación en UTI, 14(22.2%) fueron dadas de alta con embarazo en
curso, 2(3.2%) sufrieron un aborto espontáneo y 4(6.3%) muerte fetal. La FE se
produjo a los 3[1-6.75]días de la admisión.
El soporte ventilatorio máximo para las 14
pacientes que continuaron su embarazo al alta de UTI fue: cánula nasal de alto
flujo(8;57%), VMI(4;29%) y VNI (2;14%). La PaO2/FiO2 al ingreso a UTI para las
pacientes que continuaron su embarazo fue 157.5[120-240] vs. 180[100-240] para
las que requirieron FE en UTI(p0.9). Se produjeron 14 muertes
fetales-neonatales: 2 abortos espontáneos, 4 muertes fetales y 8 neonatales. De
las muertes fetales, 3 ocurrieron en fetos no viables (2 de 23 y 1 de 26.1
semanas) y 1 a una EG de 35 semanas en una paciente severamente enferma
(APACHEII=22, PaO2/FiO2=87, SOFA24=5). Los factores de riesgo de mortalidad
fetal-neonatal fueron EG a la FE (OR 0.67[0.52-0.86]p0.002) y SOFA24 (OR
1.53[1.13-2.08]p0.006). Curva ROC SOFA24 para predecir muerte fetal-neonatal:
Fig.1
Conclusiones: La mayoría de las pacientes ingresó anteparto
y recibió un cuidado prenatal mínimo; siendo éste apropiado solo en la mitad.
La principal indicación de FE fue materna y la mayoría de los recién nacidos
fue pretérmino, lo que se asoció a un número elevado de muertes neonatales. Las
muertes fetales se produjeron mayormente en fetos no viables. Los factores de
riesgo para mortalidad fetal-neonatal fueron el SOFA24 y la EG: el primero
podemos considerarlo al decidir FE y la segunda es modificable replantando las
decisiones de finalización.


M Carreño Mejia(1),
V Reyes(1), A Flores(1), G Ponnefz(1), I Corgoglioni(1), M Manosperta.(1), M
Ortega(1)
(1) San Cayetano.
La obesidad es una enfermedad de alta
prevalencia en la provincia de Buenos Aires. Se presenta este caso de un
paciente obeso mórbido al cual se le realizo una traqueostomia hibrida que
combina la técnica quirúrgica y percutánea.
Paciente masculino de 62 años con cuadro de
dificultad respiratoria, con mala evolución se evidencio desaturación,
alteración del estado de conciencia, requirió ventilación mecánica con síndrome
de distrés, se realiza evaluación antropométrica mediante mediciones indirectas
para estimar peso actual, índice de masa corporal 86,5kg/m2 peso aproximado de
250kg, posterior a las 2 primeras semanas se plantea multidisciplinariamente
con equipo de cirugía procedimiento de traqueostomía híbrida.
Se coloco analgosedacion, se deslizó el tubo
hasta colocar el neumotaponador hasta las cuerdas bucales, se realizó una
incisión vertical por debajo del cartílago cricoides, diéresis por planos hasta
exposición de anillos traqueales, se procedió con kit percutáneo seguida por la
cuerda de piano y los dilatadores sucesivos de acuerdo a la técnica seldinger,
se colocó la cánula, se procedió a realizar fijación.
La realización de la traqueostomía mediante
una técnica híbrida no se encuentra documentada ni estudiada para el
tratamiento de obeso ventilado, la traqueostomía híbrida en esta situación se
convirtió en la única opción del paciente y la imposibilidad del traslado a un
área quirúrgica, siendo un método que garantiza un buen acceso a la vía aérea
mediante un abordaje inicial quirúrgico y la técnica percutánea facilita la
realización en la misma cama del paciente; la determinación se tomo por las
dimensiones de cuello y la imposibilidad de llegar a los anillos traqueales
solo con la técnica percutánea que facilita la realización en la misma cama.
Por lo tanto se constituye en una opción segura en pacientes obesos mórbidos
con características antropométricas de difícil abordaje y con varios factores
de riesgo asociados.
0256 REPORTE DE CASO: SÍNDROME
DE ARTERIA MESENTÉRICA SUPERIOR O SINDROME DE WILKIE
V Iglesia(2), L
Peralta(1), N Tedone(2), F Villarejo(2), D Piezny(1), R Rotte(1), S
Helguera(1), D Pezzola(1), C Arias(1), L Medina(1), L Magnifico(2)
(1) Hospital
Posadas. (2) Hospital Posadas.
Introducción: El síndrome de la arteria mesentérica
superior, o de Wilkie, es una condición poco frecuente de obstrucción del
tracto digestivo superior. Sucede por una compresión extrínseca en la cara
anterior de la tercera porción del duodeno a su paso entre el ángulo formado
por la arteria mesentérica superior y la aorta y la columna vertebral. La
severidad de los síntomas se correlaciona con la distancia aortomesentérica. La
incidencia varía entre 0,013 al 3%, pero la tasa de mortalidad aumenta a 33% si
se retrasa el diagnóstico. La etiopatogenia puede ser congénita o adquirida,
siendo ésta última la de mayor presentación.
Presentación del caso: paciente sexo biológico masculino, 27 años. Como antecedentes
presenta: meduloblastoma de fosa posterior con tratamiento quirúrgico,
radioterapia y quimioterapia, insuficiencia hipofisaria múltiple, derivación ventrículo-peritoneal
y ventrículo-atrial por hidrocefalia e hipoacusia. Ingresa por dolor abdominal
asociado a vómitos porráceos y al examen físico con reacción peritoneal. Se
realiza TAC que evidencia líquido libre, distensión gástrica y duodenal. Se decide
conducta quirúrgica por peritonitis generalizada y úlcera duodenal perforada.
Por imposibilidad de progresión de sonda para alimentación, se realiza
yeyunostomía. Cursa posoperatorio inmediato en Unidad de Cuidados Críticos
(UCC) con requerimiento de vasopresores y ARM. Evoluciona de manera tórpida,
con abundante débito por SNG y alcalosis metabólica persistente. Requiere plan
de hidratación parenteral amplio y optimización de medio interno a diario
secundario al alto débito (> 1500 ml). Con el informe final de TAC se
evidenció ángulo aortomesentérico de 19,7° y una distancia aortomesentérica de
7,57mm. Se realiza recuperación nutricional prequirúrgica y se decide realizar
duodenoyeyuno anastomosis con plastia de pared con malla.
Discusión: La elección de la cirugía para derivar la
obstrucción es exitosa en un 90 % de los casos reportados. En nuestro caso la
presentación clínica se correlacionó en la mayoría de lo descripto en la
literatura. Hasta la fecha la paciente continua en UCC por otras complicaciones
no asociadas a este síndrome.
Conclusión: Un diagnóstico rápido permitió instaurar un
adecuado soporte nutricional para mejorar valores bioquímicos nutricionales
alterados previo a la intervención quirúrgica y reducir el riesgo de
mortalidad.
GA Plotnikow(1), DS
Villalba(2), E Perez Calvo(2), C Quiroga(3), E Navarro(4), E Gogniat(5)
(1) Hospital Británico De Bs As. (2) Clínica Basilea.
(3) Sanatorio Anchorena Recoleta. (4) Centro Del Parque. (5) Capítulo De
Kineisología Intensivista.
Introducción: La oxigenoterapia a alto flujo a través de
cánulas nasales genera cambios fisiológicos que impactan en las variables ventilatorias
de los pacientes. Sin embargo, sabemos que existen efectos perjudiciales en la
mucosa de las vías respiratorias relacionados con la inhalación de gases
desacondicionados. El objetivo de este estudio fue evaluar el rendimiento en
términos de humedad absoluta (Hab), humedad relativa (HR) y temperatura (T°) de
diferentes marcas de humidificadores activos (HH) y circuitos calefaccionados
en modo invasivo durante el uso de oxigenoterapia de alto flujo entre 30 y 100
L/min.
Métodos: Estudio observacional prospectivo realizado
en el laboratorio de análisis de equipos de un sanatorio de Buenos Aires; del 5
de septiembre al 20 de octubre de 2019.
Resultados: Se encontró
una interacción estadísticamente significativa entre los flujos flujos
programados y las diferentes combinaciones de HH y circuitos para la entrega de
Hab (P<0,001) (Tabla 1). Entre las diferentes combinaciones, el HH
Fisher&Paykel MR850 con el circuito Medtronic-DAR (HA1CIR3) fue el de mejor
rendimiento (Hab: 43.6±4.4 mg/L), sin diferencias significativas con el mismo
HH y el circuito Intersurgical (HA2CIR5, p=0.915), el circuito AquaVENT
(HA1CIR6, p=0.144) y el circuito GGM (HA1CIR7, p=0.342) (Figura 1).
También se encontró un efecto del flujo sobre
la Hab entregada, independientemente de la combinación de HH y circuitos
(P<0,001). Sin embargo, en el modo invasivo, la combinación del HH
Fisher&Paykel MR850 con el circuito Medtronic-Dar, el circuito
Intersurgical y el circuito AquaVENT siempre alcanzó valores de Hab >33
mg/L, incluso con flujos de hasta 100L/min. La combinación del HH Flexicare
FL9000 con el circuito Fisher&Paykel RT202, el circuito Fisher&Paykel
Evaqua 2, el circuito Flexicare, el circuito AquaVENT y el circuito GGM
consiguieron resultados similares.
Conclusiones: Cuando se utilizaron HH en el modo invasivo
para la implementación de oxigenoterapia a alto flujo, la Hab dependió no sólo
de los humidificadores y la combinación de circuitos, sino también del flujo
programado, especialmente en flujos >50L/min. Además, los HH mostraron
diferentes comportamientos, en algunos casos ineficientes, a la hora de
proporcionar una humidificación adecuada. Sin embargo, algunos equipos
mejoraron su rendimiento cuando se ajustaron al modo invasivo.


C Pisarello(5), JE
Alfonso(1), H Alvarez(1), EA Fernandez Da Veiga(1), MR Sanabria(1), R
Garcia(2), V Lezcano(3), L Fernandez(4), M Dickau(4), LB Costa(5), S Doval(6),
A Ramirez(6), A Ruiz Diaz(7)
(1) Cucaicor. (2) Hospital Angela I. De
Llano. (3) Hospital San Juan Bautista. (4) Hospital Juan Pablo Ii. (5) Hospital
Escuela Gral. San Martin. (6) Hospital San José. (7) Hospital Muniagurria.
Introducción: El número de pacientes que esperan un
trasplante de pulmón es mayor que el número de pulmones de donantes adecuados,
siendo la tasa de recuperación pulmonar menor en comparación con otros órganos
sólidos.
Material y Métodos: Estudio observacional, retrospectivo,
descriptivo, llevado a cabo entre enero 2019 y agosto del 2022. Se incluyeron
donantes pulmonares. El análisis estadístico se llevo a cabo con el programa
SPSS.
Resultados: Se han procurado 294 órganos sólidos con
fines de trasplantes en la Provincia de Corrientes. El riñón fue el órgano más
ablacionado (67.7%), seguido del hígado (17.3%) y el corazón (8.2%). La
procuración de pulmón representó el 3% de los órganos ablacionados (7 pulmón
Bilateral / 2 Pulmones Unilateral). En Argentina, se han ablacionados en total
75 pulmones, de los cuales, la provincia, aportó el 12%, siendo la tercera a
nivel país. En cuanto a los establecimientos de origen, el Hospital Escuela
J.F. San Martin, ha sido la segunda institución generadora de donantes
pulmonares durante los últimos 3 años, obteniéndose además dos donantes en el
Hospital Muniagurria de Goya. En el análisis de los donantes pulmonares, la
media de edad fue de 28 ± 11 años. El sexo masculino representó el 57%. Media de
días de ventilación mecánica 2 ± 1 días. Los donantes han sido ventilados con
estrategia ventilatoria protectiva (6-7 ml/kg peso teórico) PEEP 5-8 cmH20, la
media de pO2/FIO2 fue de 479 ± 77. Media de tiempo de isquémia fría 6,7 ± 1
horas y de isquémia caliente 43 ± 15 minutos.
Discusión: Actualmente 276 argentinos están en lista
para trasplante pulmonar, y la procuración representa solamente el 7.2% de la
demanda.
Conclusión: Nuestro estudio tiene como objetivo motivar a
las provincias a llevar a cabo con mayor frecuencia la procuración pulmonar.
0261 IMPLEMENTACION DE CANULA
NASAL DE ALTO FLUJO EN PANDEMIA COVID-19
A Gira(1), E
Bellone(1), V Pousa(1), P Pratesi(1)
(1) Universitario Austral.
Introducción: La cánula nasal de alto flujo (CNAF), posee
una recomendación fuerte para ser usado en pacientes diagnosticados con
COVID-19 que presentan falla respiratoria hipoxemica, la misma es elegida sobre
otras formas de Ventilación No invasiva, entre sus beneficios permite el
monitoreo activo para identificar signos de empeoramiento.
Al comienzo de la pandemia existían dudas si
era de alto riesgo para el personal de salud, y beneficiosa para el paciente,
con estudios posteriores pudo determinarse que su uso es seguro para el
personal de salud con uso adecuado de EPP y existe evidencia que aumenta los
días libre de Ventilación mecánica invasiva y disminución en los días libres de
UCI.
Objetivo: Describir el número de pacientes en los
cuales se implementó CNAF y que no requirieron ingreso a UCI
Describir en pacientes con Neumonia COVID-19
la mortalidad global y la de pacientes ventilados.
IMPLEMENTACION DE UNA SISTEMATICA DE CNAF
DURANTE LA PANDEMIA COVID-19
Se implementó un algoritmo para definir el
uso de CNAF en pacientes con Neumonía COVID-19 que ingresaron en el Hospital
Austral. En la sistemática se involucraron los servicios de: Emergencias,
Clínica medica, UTIM, terapia intensiva.
Población: Pacientes adultos con Neumonía COVID-19
internados en Hospital Austral entre mayo del 2020 y Julio 2021.
Análisis y resultados: En el Hospital Austral 130 pacientes usaron
CNAF, 60 (46%) no requirieron UCI.
En la UCI adultos, de 262 pacientes un 25%
(65 pacientes) requirió ARM y un 75% (197 pacientes) CNAF.
De los 197 pacientes con CNAF, 56 (29%) no
requirió Intubación orotraqueal (IOT). El promedio de días de CNAF fue de 5
días, el promedio de días de CNAF que no requirió IOT fue de 7,8 y el promedio
de días de quienes usaron CNAF hasta IOT fue de 3,5.
La mortalidad global fue del 19% y la
mortalidad en pacientes ventilados del 24%.
Conclusión: El uso de CNAF en pacientes con Neumonía
COVID es seguro, genera beneficio para el paciente, disminuye el ingreso a UCI
y a Ventilación mecánica invasiva, la mejor forma de implementarlo es mediante
un protocolo institucional, interdisciplinario y transversal.

0263 PARO CARDIORRESPIRATORIO
RECUPERADO SECUNDARIO A SÍNDROME DE TAKOTSUBO. PRESENTACIÓN DE CASO
GM Garelli(1), SB
Soli(1), JJ Storani(1), DS Diaz(1)
(1) Hospital Italiano Rosario.
Introducción: El Síndrome de Takotsubo, es una entidad poco
usual, más frecuente en mujeres. Un factor estresante actuaría como
desencadenante. Su pronóstico es benigno, en general con regresión completa.
Caso clínico: Paciente femenino, 42 años, sin antecedentes.
Ingresó a UTI por paro cardiorrespiratorio recuperado en contexto de riña
callejera. Ambulancia constató ritmo de FV, realizó cardioversión eléctrica.
Ingresó sedada, con intubación orotraqueal, taquicárdica, hipotensa, signos de
hipoperfusión periférica. Al ingreso: ECG: ritmo sinusal, FC 135lpm,
infradesnivel del ST de V3-V6. LABORATORIO: TGO 219U/L, TGP 268U/L, CPK 916U/I,
CPK MB 44,9U/I, LDH 846U/L, acidosis metabólica moderada, láctato 2,8mm/L,
Troponina I 1615pg/ml, resto normal. RX TORAX normal. ECOCARDIOGRAMA discinesia
apical, septum y cara anterior, FEVI 30%. CCG y RMI cardíaca normales. Realizó
tratamiento con noradrenalina, dobutamina. Al día 3 se suspenden los
vasoactivos. Mejora laboratorio. Suspende sedación al día 4 y se extuba al día
6 y pasa a sala el día 8. Seguimiento a las 8 semanas con estudios normales.
Discusión: El Síndrome de Takotsubo es una
miocardiopatía de causa desconocida, con disfunción sistólica temporal y
reversible del VI, sin evidencia de enfermedad coronaria. Suele manifestarse
con dolor precordial y disnea, menos del 3%, arritmias, paro cardíaco y shock
cardiogénico como en nuestro caso. El 50% presenta estrés físico o emocional.
Son característicos: elevaciones modestas de las enzimas cardíacas; ECG ritmo
sinusal (90%), elevación del segmento ST (44%), descenso del ST (8%) o
alteraciones en la repolarización; en ecocardiograma alteración de la
contractilidad reversible y más común en zona apical, FEVI reducida (86%). Es
imprescindible la cinecoronariografía sin lesiones obstructivas significativas
para confirmar el diagnóstico. El tratamiento es soporte hemodinámico,
prevención de complicaciones y anticoagulación si se evidencia trombo
intracardíaco. La recuperación suele ser completa en días o semanas. Es posible
la recurrencia.
Conclusión: Motiva la presentación del caso, dar a
conocer una entidad poco frecuente en la terapia intensiva, muchas veces
subdiagnosticada. Con gran similitud con el síndrome coronario agudo, sin
embargo, con mejor evolución y pronóstico.
M Pazmino(1), R
Alvarez(1), J Velez(1), C Fridman(1)
(1) Español.
Introducción: Lupus Eritematoso Sistémico (LES), trastorno
infrecuente, cuyo pronóstico depende del compromiso renal y neurológico,
afectando hasta 40% de los casos, generalmente es tardío y se correlaciona con
gravedad.
El estado epiléptico es una urgencia
neurológica de etiología variable, frecuente en niños, con alta morbimortalidad
y elevado riesgo de secuelas, que requiere tratamiento agresivo una vez
identificado ya que el tiempo de convulsión es determinante para la falta de
respuesta. El estado super refractario no responde al tratamiento habitual
inicial, con insuficiente evidencia para guiar el tratamiento de tercera línea.
Objetivos: Describir las características clínicas,
exámenes complementarios y tratamiento empleado en una paciente con diagnóstico
de LES con compromiso neurológico severo.
Descripción: Niña de 12 años, con diagnóstico de LES
recientemente, recibió metilprednisolona e hidroxicloroquina. Hace 48 horas
presenta crisis de ausencia y temblor, luego estatus convulsivo resistente al
tratamiento de primera y segunda línea, induciendo coma farmacológico escalando
a midazolam y tiopental a dosis máxima, además recibió gammaglobulina, con
regular respuesta. Presentó focos epileptógenos con tendencia a la
generalización al intentar descender benzodiacepinas, agregándose topiramato,
actualmente en plan de dieta cetogénica.
Inicialmente presentó leucopenia y
neutropenia con compromiso de enzimas hepáticas, y en LCR ligera pleocitosis e
hiperproteinorraquia, y se medicó con Ceftriaxona y Aciclovir. La TC de encéfalo
sin hallazgos relevantes. Durante su internación presentó injuria renal aguda
transitoria.
El diagnóstico diferencial fue amplio y se
incluyeron causas infecciosas, metabólicas e hipertensión, la punción lumbar
con características similares a la literatura determinando permeabilidad de
barrera hematoencefálica por aumento de factores inflamatorios en LCR. El
monitoreo electroencefalográfico es indispensable. Las neuroimágenes indicadas
en este proceso son RMN y angioresonancia.
Conclusión: El status epiléptico super refractario, es de
difícil manejo, sin embargo su manifestación infiere gravedad y no debe
posponerse su tratamiento intensivo con corticoides endovenosos a altas dosis,
debido al riesgo vital que conlleva. En casos de respuesta pobre y en contexto
de LES se puede combinar con inmunosupresores, gammaglobulina, dieta cetogénica
y otros tratamientos nuevos como el rituximab e inclusive medicación
intratecal, sin evidencia concluyente y siempre con pronóstico ominoso en la
mayoría de los casos.
A Couso(1), S
Benavides(1), A Canedo Bermudez(1), M Ortiz(1), S Pello(1), F Amieva(1), M
Ducasa(1), V Picolla(1), G Ramos(1), CB Cozzani(1)
(1) Dr Cosme Argerich.
Introducción: La falla ventricular derecha aguda se asocia
con una alta prevalencia a infarto de miocardio o tromboembolismo de pulmón. Se
presenta un caso en el contexto de shock hipovolémico y secundario a una
reanimación con fluidos excesiva, siendo una complicación poco habitual,
implicando un desafío diagnóstico y terapéutico.
Caso clínico: Paciente femenina de 25 años, sin
antecedentes de relevancia, cursando internación por pancreatitis biliar con
colestasis por lo que requirió colecistectomía laparoscópica. Evoluciona en el
postoperatorio inmediato con shock hipovolémico sin respuesta a reanimación con
fluidos, evidenciándose líquido libre en cavidad por lo que requiere
laparotomía exploradora evidenciándose hemoperitoneo y hematoma perihepático,
realizándose packing del lecho. En el postoperatorio persiste con inestabilidad
hemodinámica, aumento de noradrenalina, y oligoanuria, requiriendo re
exploración, recambio de packing, siendo transfundida nuevamente, agregando en
el postoperatorio, soporte con vasopresina, deterioro de la PAFI y signos de
sobrecarga. Posteriormente se realiza ecocardiografía con evidencia de
disfunción y dilatación severa del ventrículo derecho (con angiotomografía de
tórax negativa para TEP), iniciando soporte inotrópico con milrinona y
hemofiltración. En menos de 24 hs, se suspende drogas vasoactivas y diuréticos,
con restauración de la función ventricular derecha ad integrum.
Discusión: El ventrículo derecho depende de una poscarga
disminuida con mayor volumen telediastólico. La falla ventricular derecha se
genera por incremento de la resistencia del circuito pulmonar, o disfunción
contráctil miocárdica intrínseca. El aumento de tensión parietal por sobrecarga
genera alteración de la perfusión iniciando un círculo vicioso hacia la
claudicación. La reanimación agresiva, el aumento de las resistencias
pulmonares en el contexto de hipoxemia y la descompresión de la vena cava en
contexto del recambio del packing , podrían explicar la falla ventricular de
esta paciente. Este escenario no es infrecuente en el entorno de los cuidados
intensivos posquirúrgicos.
Conclusión: Es de vital importancia el manejo cauteloso
en la fluidoterapia, buscando limitar los aportes una vez superado el período
de reanimación inicial, además de la sospecha temprana de otros mecanismos de
shock. Frente a la presencia de shock cardiogénico con falla del ventrículo
derecho, el presente caso resalta la importancia de considerar la sobrecarga
como una etiología posible.
PN Rubatto Birri(1),
R Giannoni(2), M Furche(3), M Nahra(4), MG Arce Gallardo(2), G Segui(5), G
Tuhay(6), P Birri(7), M Romano(8), M Humacata(9), V Petrochelli(10), L
Huespe(11), D Banegas(12), A Gomez(3), G Zakalik(13), F Lipovesky(14), P
Montefiore(15), C Galleti(16), J Pendino(17), M Vera(18), S Mare(19), L
Bergallo(20), G Fernandez(21), ML Campassi(22), F Rios(23)
(1) Sanatorio Otamendi. (2) Ramon Carrillo.
(3) De Los Arcos. (4) Español. (5) Haedo. (6) Fundación Favaloro. (7) Sanatorio
Sucre. (8) San Agustin. (9) San Bernardo. (10) Integral De Salud. (11) General
San Martin. (12) Otamendi. (13) Luis C. Laggomagiore. (14) Univesidad
Interamericana. (15) San Martin. (16) Allende. (17) Centenario. (18) Central.
(19) Zonal Esquel. (20) Mapaci. (21) Pueyrredon. (22) Pequeña Familia. (23) Las
Lomas.
Introducción: La insuficiencia renal aguda (IRA) es un
síndrome frecuente en la UTI, asociado a importante morbi-mortalidad. En
Argentina la información al respecto es escasa; el objetivo de este estudio fue
caracterizar la epidemiología, pronóstico y tratamiento en pacientes con IRA en
la UTI.
Métodos: Estudio multicéntrico de cohorte prospectivo,
que incluyó pacientes internados en 35 UTIs entre 1/6/2018-31/12/2018. Se
recolectaron datos en la admisión y durante la internación. IRA se definió
según KDIGO 2012. Se exploraron incidencia, factores de riesgo y mortalidad de
IRA a los 60 dias en comparación con los pacientes sin IRA (no-IRA). Se analizó
la IRA al ingreso (IRA1), y la desarrollada durante la internación (IRA2).
Resultados: Se incluyeron 1466 pacientes; la IRA ocurrió
en 61.3% (900/1466). En la Tabla 1 se presentan factores de riesgo para el
desarrollo de IRA, que fueron: edad, BMI, Hipertensión, otras enfermedades
cardiovasculares, diabetes, SOFA, APACHE II, deshidratación, sepsis, uso de
vasopresores e inotrópicos, administración de radiocontraste, diuresis horaria
en las 12 horas previas y uso de ventilación mecánica. La distribución de
estadios de gravedad fue: KDIGO1 (47.6%), KDIGO2 (28.5%) y KDIGO3 (24.1%). La
IRA1 representó 72.6% de los casos e IRA2, 27.3%. Se utilizaron terapias de
reemplazo renal (TRR) en 14.8% (134/900) de los pacientes, siendo más frecuente
en IRA2 (76.9%) vs. IRA1 (23.1%). La mortalidad fue 37.8% vs. 23.3% (IRA vs.
No-IRA, p=0.000); y de 37.8% vs. 41.2 % en IRA1 vs. IRA2 (p=0.53), respectivamente.
La IRA2 ocurrió a los 6 +/- 2.5 días de internación en UTI y se identificaron
como factores de riesgo: el BMI y el uso de contraste.
Conclusiones: La IRA representa un problema de salud en las
UTIs argentinas, con gran incidencia y mortalidad. La IRA al ingreso fue más
frecuente que la desarrollada en la UTI, con igual pronóstico. Los factores de
riesgo para IRA, y la utilización de TRR fueron semejantes a los descriptos en
otros estudios epidemiológicos. Asimismo, la distribución de los estadios KDIGO
2012 es similar a lo descripto en la literatura.


0268 HALLAZGOS TOMOGRAFICOS
ATÍPICOS EN PACIENTES COVID 19 Y SU
ASOCIACIÓN CON TOCILIZUMAB
DN Gauna(1), A
Dubin(1), N Benassich(1), C Zapata(1), A Leporace(1), C Alquichire(1), R
Bastidas(1), M Palmas(1), P De Leon(1), I Swoboda(1), A Guevara(1), S
Gallego(1), L Sambrana(1), G Lopez(1), D Colosima(1), V Kanoore Edul(1), N
Rubatto(1), M Mugno(1)
(1) Sanatorio Otamendi.
Introducción: El síndrome de distress respiratorio agudo
(SDRA) es una de las complicaciones más severas de los pacientes con
enfermedad por virus SARS-Cov-2 (COVID-19) y está asociado a alta mortalidad.
En estos pacientes, se ha demostrado un estado de inflamación sistémica, con
niveles elevados de citoquinas pro-inflamatorias, como las interleukinas 1
(IL-1), 6 (IL-6), el Dímero-D y otros reactantes de fase aguda.
El Tocilizumab, un anticuerpo humanizado
contra el receptor de IL-6, ha demostrado mejorar la evolución y disminuir la
mortalidad, posiblemente por modular la respuesta inflamatoria. Sin embargo, a
partir de la utilización sistemática de este inhibidor, en ciertos pacientes
hemos notado el desarrollo de grandes cavitaciones pulmonares.
Objetivo: El objetivo de este estudio es describir la
incidencia de cavitaciones pulmonares en pacientes con neumonía por COVID-19 y
estudiar su posible asociación con el uso de Tocilizumab.
Métodos: Diseño: Cohorte retrospectiva de datos
recolectados prospectivamente.
Población: Pacientes con SDRA por COVID-19
internados en UTI durante la Pandemia COVID-19 en Argentina
Exposición: Pacientes que recibieron
Tocilizumab versus tratamiento estándar (corticoides).
Datos: se recolectaron datos epidemiológicos,
parámetros respiratorios, hemodinámicos, fallas orgánicas, escores de gravedad,
requerimientos de ventiliación mecánica (VM) y parámetros de evolución como
enfermedad tromboembólica, infecciones nosocomiales, cavitaciones pulmonares y
mortalidad en UTI y hospitalaria.
Plan estadístico: Se resumieron variables en
media, mediana y promedios de acuerdo al tipo y distribución. Se compararon las
muestras con test de χ2 y riesgo relativo. Se consideró un valor de
significancia del 5%.
Resultados: Desde el
20/04/2020 al 26/07/2022 ingresaron a UTI 813 pacientes, 320 (39%) con
diagnóstico de COVID-19 grave. En un subgrupo de 222 pacientes (69%), se
realizó al menos una tomografía de tórax. Cincuenta y ocho pacientes (26%)
recibieron Tocilizumab. Se hallaron cavitaciones en 15 pacientes (7%), de los
cuales 8 (53%) habían recibido Tocilizumab (tabla 1). Esta asociación resultó
mayor que en los pacientes sin exposición a la droga (χ2 =6.17, p=0.013).
Discusión: Las cavitaciones pulmonares son
complicaciones infrecuentes relacionadas a enfermedades infecciosas y
tromboembolia. En esta cohorte, sin embargo, encontramos un aumento de casos en
pacientes que recibieron Tocilizumab.
Conclusión: El uso de Tociluzumab en pacientes con SDRA
por COVID-19 se asoció al desarrollo de cavitaciones pulmonares

G Gonzalez(1), F
Pavone(1), A Lepore(1), PZ Vladimir(1), M Ludueña(1), A Guillermo(1), A Maria
Fernanda(1), M Pablo(1), L Marta(1)
(1) Churruca.
Introducción: El síndrome de ALCAPA proveniente de las
siglas en inglés (Anomalous origin of the left coronary artery from the
pulmonary artery), es un raro defecto congénito, la arteria coronaria izquierda
nace del tronco de la arteria pulmonar, también conocido como Síndrome de
Bland-White-Garland. Representa el 0.25 al 0.5% de las cardiopatías congénitas
con una prevalencia de 1 en 300000, siendo la alteración coronaria más frecuente.
Presentación del caso: Paciente de 3 meses de vida, RNTPAEG, que
consulta por tos y dificultad respiratoria. SV FC: 160 x min, FR 70 x min, TA
80/42 TAM 54, SAT 97% con CAFO, Tax 37ºC. Presenta palidez cutánea mucosa,
tiraje subcostal, espiración prolongada, rales subcrepitantes bilaterales,
ruidos cardiacos hipofonéticos, relleno capilar de 3”, no soplos, no r3 ni r4.
PELOD 2 (7- MP 3.5%). PIM 3 (-1.52- PM 17.93%). La rx tx presenta cardiomegalia
severa y congestión pulmonar. Por inestabilidad hemodinámica se decide ARM. El
ecocardiograma muestra DDVI: 47 mm DSVI 37 mm FA: 21% FE 35% CD 3 mm (z 5) CI
2,3mm (z 4) saliendo de la pulmonar. IM moderada a severa IT leve. Lab: NT-PROBNP
> 25000 (vn < 125 pg/ml) Troponina US 156.5 (vn: < 19 ng/L). ECG QR en DI- AVL-V5-V6. Se decide realizar
Angiografía selectiva en coronaria derecha: observándose CD con calibre
aumentado y circulación colateral escasa, el tronco de la CI nace del tronco de
la arteria pulmonar que roba el flujo. Decidiéndose la corrección quirúrgica
Discusión: El ALCAPA es una patología poco frecuente,
que debe sospecharse en todo paciente con dilatación de cavidades izquierda, y
ECG compatible, su diagnóstico precoz y corrección quirúrgica aumenta la
sobrevida de los pacientes, que sin tratamiento solo un 10-15% desarrollan
colaterales permitiendo la sobrevida hasta los 30-40 años. La ecocardiografía a
la cabecera del paciente es el primer método diagnóstico, sin embargo la
angiografía selectiva nos permite evaluar no solo la salida de la CI sino también
las colaterales.
Conclusiones: El ALCAPA es infrecuente. Su diagnóstico
precoz mejora la sobrevida. La reimplantación quirúrgica de la CI es el
tratamiento. Si el miocardio esta hibernado, la función ventricular es normal
con el tiempo.


0270 Glomerulonefritis:
Presentacion atipica
A Gonzalez(1), G
Tocalli(1), A Baez(1), M Lotorto(1), C Canteli(2), S Lujan(1)
(1) Hospital Privado De Rosario. (2) Hopital
Privado De Rosario.
Introduccion: La glomerulonefritis es un grupo de
trastornos que se presentan con hematuria, proteinuria, hipertensión y
reducción de la función renal. Histologicamente se clasifican en proliferativas
y no proliferativas, dentro de las proliferativas se encuentra la membranoproliferativa
(GNMP). La GNMP tipo I es mediada por inmunocomplejos aunque la identidad del
antígeno se desconoce habitualmente. La GNMP tipo II se caracteriza por
depósitos densos que no contienen inmunoglobulinas pero se cree que activan el
complemento.
Caso clínico: Mujer de 52 años con antecedente de ACV
isquémico, gota, etilismo, depresión, enfermedad por covid-19 leve. Consulta
por cuadro de 4 dias de evolución de fiebre, desorientación, deterioro del
sensorio progresivo, diarrea y oliguria. Al examen físico paciente febril,
hipotensa, somnolienta, apertura ocular al estimulo verbal, no comprende ni
ejecuta ordenes, sin foco motor, PIRS, RASH cutáneo generalizado que desaparece
a la vitropresion. Laboratorio: Gb: 23.540 (71/17/0.3/5.7/5.4), Hb: 12.7, Hto:
36.1, Plaquetas: 323.000, Uremia: 346, Creatinina: 8.6, Fal: 608, Ggt: 383,
Iono: 134/6.5, EAB: 7.26/15/114/-18/6.6/97%. Toxina para clostridium difficile
positiva. TAC de craneo, RMI de encéfalo, LCR, serologías virales, cultivos microbiologicos,
panel inmunologico, ecografía renovesical y laboratorio metabolico sin
particularidades. Se inicia tratamiento antibiotico empirico con vancomicina,
ceftriaxona, ampicilina y vancomicina via oral y hemodiálisis de urgencia.
Presenta buena evolución con persistencia de IRA AKI III por lo que se realiza
biopsia renal con diagnóstico de glomerulonefritis membranoproliferativa por
depósito de IgG y C3. Realizó pulsos de esteroides con mejoría de parámetros de
laboratorio, y cese de terapia de reemplazo renal. Intercurre con nueva
alteración del sensorio y desorientacion, se realiza TAC de craneo que
evidencia lesión hemorrágica periventricular izquierda con vuelco a ventrículo
lateral homolateral. Asociado a anemia, plaquetopenia y aumento de LDH con
sospecha de MAT vs SHU.
Discusion: En este caso fue un gran desafio el
diagnostico de certeza, excleyendo los diagnosticos diferenciales mas
frecuentes como sindrome de DRESS, meningoencefalitis, MAT, SHU. Siendo
fundamental la biopsia renal en el diagnostico etiologico.
Conclusión: Motiva la presentación de este caso la baja
incidencia y la importancia del diagnóstico temprano a fin de disminuir la
morbimortalidad.
M Busico(1), M
Busico(2), NA Fuentes(3), A Gallardo(4), A Vitali(5), J Quintana(2), M
Olmos(3), M Esperatti(3)
(1) Clinica Olivos. (2) Clinica Olivos Smg.
(3) Hospital Privado De Comunidad. (4) Sanatorio Clínica Modelo De Morón. (5)
Sanatorio De La Trinidad Palermo.
Introducción: En la construcción de la definición de Berlín
de SDRA se consideró factibilidad, confiabilidad, validez de contenido y
validez predictiva, considerando la muerte como desenlace final. La inclusión
en la definición de los pacientes con requerimiento de cánula nasal de alto
flujo (CNAF) y criterios de SDRA ha sido debatida, sin embargo, su validez
predictiva no ha sido determinada. Nosotros evaluamos la validez predictiva de
la definición de Berlín en pacientes con insuficiencia respiratoria secundaria
a COVID-19, requerimiento de CNAF y criterios de SDRA. Adicionalmente evaluamos
éste parámetro en subgrupos específicos y los días libres de soporte
ventilatorio al día 28 (DLSV) en cada grupo de severidad.
Métodos: En éste estudio de cohorte multicéntrico y
prospectivo en 6 UCIs de Argentina se incluyeron consecutivamente pacientes
>18 años con COVID-19 y requerimiento de CNAF desde junio-2020 a
diciembre-2021. Criterios de Inclusión: a) EAB dentro de las 24hs de iniciada
la CNAF; b) PaO2/FiO2.
Resultados: Se incluyeron 696 pacientes. En la tabla 1 se
muestran las características de la población y los desenlaces clínicos
relevantes. El AUROC para mortalidad al día 28 fue 0.606(IC95%0.561-0.651); con
la inclusión del sexo y la edad en el modelo de regresión, el AUROC se
incrementó a 0.748(IC95%0.705-0.791)p.
Conclusiones: La validez predictiva de la definición de
SDRA aplicada a pacientes con COVID-19 y requerimiento de CNAF fue similar a la
de la definición original de Berlín -AUROC:0.57(IC95% 0.561-0.593)-. Asumiendo
que los criterios de factibilidad, confiabilidad y validez de contenido son
aplicables a la población evaluada, estos resultados respaldan el uso de la
definición en este subgrupo de pacientes.


ML Morales(1), L
Ruarte(1), M Garcia(1), P Taborda(1), J Ortega(1), A Quinteros(1), S Rojas(1),
C Ferreyra(1), D Carranza(1), N Bonetto(1), S Carrizo(1), J Celia(1), M Ruiz(1),
M Buemo(1)
(1) Regional Victor Sanguinetti.
Introducción: Los trastornos gastrointestinales son
frecuentes en los pacientes críticos. La constipación es una complicación no
estudiada asociada a resultados clínicos desfavorables. Es marcador de severidad
y pronostico.
El objetivo general del trabajo fue estimar
la prevalencia de constipación en la Unidad de Terapia Intensiva Adultos (UTIA)
del Hospital Regional de Comodoro Rivadavia durante el periodo enero 2022 a
junio 2022.
Los objetivos específicos fueron determinar
el tiempo transcurrido hasta el inicio de la alimentación enteral (AE),
deposiciones y tratamiento con catárticos.
Metodología: El diseño es descriptivo, prospectivo y
transversal. Basado en la recolección datos de historias clínicas durante enero
a junio 2022. Definiéndose constipación la ausencia de movimientos intestinales
durante 72hs o necesidad de recurrir a medidas evacuantes.
Variables estudiadas: edad, sexo,
antecedentes de constipación y tratamiento, motivo de ingreso, evolución, días
totales de internación, APACHE y SOFA, deposiciones y tratamiento con
catárticos, inicio de AE, requerimiento de vasoactivos, opioides, bloqueantes
neuromusculares.
Criterios de inclusión: mayores de 18 años, 5
o más días de internación, requerimiento de AVM durante 3 días, portadores de
sonda nasogástrica y AE.
Resultados: El total de ingresos fue 177 pacientes, 44
cumplían con criterios de inclusión. El promedio de internación fue de 13 días,
21 fallecieron y 23 fueron dados de alta. La edad media fue 59 años, 28
masculinos y 16 femeninos. El principal motivo de ingreso fue medico (28),
luego neurológico (14) y quirúrgico (2).
Respecto a los antecedentes de constipación
26 lo desconocían, lo negaban 14 y solo 4 lo confirmaron, ninguno realizaba
tratamiento.
La prevalencia de constipación fue 91%.
Discusión: La constipación es una patología frecuente.
La mayoría de los fallecidos cursaron con constipación, algunos nunca tuvieron
deposiciones. El SOFA fue mayor al promedio.
Nuestro servicio elaboró un protocolo basado
en una revisión bibliográfica. A pesar de su existencia, se evidencio una alta
prevalencia de esta patología.
Se recomienda iniciar AE en las primeras 48hs
de ingreso como factor de prevención, al día 3 el 95% de la muestra la había
iniciado. Creemos que es fundamental revisar el protocolo junto al personal del
servicio y luego verificar su cumplimiento.


0275 Uso de HELMET como
herramienta terapéutica en pacientes con neumonía por COVID-19
JP Arduino(1), S
Pulcinelli(1), D Souto(1), D Sanchez(1), D Cattalini(1)
(1) Heca.
Objetivos: Evaluar el uso de HELMET como herramienta
terapéutica en cuadros de insuficiencia respiratoria, que no requieran
ventilación mecánica invasiva.
Material y métodos: Durante la pandemia se admitieron 349
pacientes a UTI, de los cuales 209 tuvieron diagnóstico de COVID 19. De estos
190 requirieron asistencia ventilatoria, a 149 se los colocó en ventilación
invasiva al momento del ingreso a la unidad, mientras que a 41 pacientes se los
vinculó a VNI con Helmet.
Resultados: De los 41 pacientes tratados con Helmet, 63%
fueron hombres y 37% mujeres, con una edad promedio de 49 años. La mortalidad
observada en este grupo fue del 39% La estadía promedio fue de 14,7 días, con
un promedio de uso de Helmet de 4,7 días.
“De los 209 pacientes con diagnóstico de
COVID, el 65% fueron hombres y el 35% mujeres, con una edad promedio de 50,2
años. El 88,2% presentaron algún tipo de comorbilidad. La mortalidad total observada
en nuestro Servicio fue del 51% en pacientes admitidos por COVID-19; siendo la
mortalidad en los pacientes con ventilación invasiva del 61,9%. De los 41
pacientes tratados con Helmet, 63% fueron hombres y 37% mujeres, con una edad
promedio de 49 años. En 18 de los 41 pacientes en los que se implemento esta
terapéutica se observó una evolución favorable, no requirieron VI. La
mortalidad observada en este grupo fue del 39% (23 pacientes requirieron VI, de
los cuáles 16 fallecieron). La estadía promedio fue de 14,7 días, con un
promedio de uso de Helmet de 4,7 días.”
Palabras Claves: COVID, insuficiencia respiratoria,
ventilación invasiva, helmet.
M Accoce(1), J
Pérez(1), J Dorado(1), D Gilgado(1), G Cardoso(1), M Bertozzi(1), A Vitale(1),
C Papazian(1), M Calvo Delfino(1), C Snaider(1), R Bragagnolo(1)
(1) Sanatorio Anchorena De San Martín.
Introducción: La reducción de la mortalidad en síndrome de
distrés respiratorio moderado-grave por coronavirus-19 (C-ARDS) mediada por el
uso de decúbito prono (DP) podría deberse a la atenuación de la lesión pulmonar
inducida por el ventilador (VILI) [1]. El mechanical power(MP) ha sido
propuesto como una variable que refleja el riesgo de VILI [2]. Sin embargo, los
cambios en la elastancia de la caja torácica (ECT) inducido por el DP podrían
influir sobre el MP afectando su capacidad para identificar la respuesta a la
intervención. Nuestro objetivo fue analizar el efecto del primer ciclo de DP en
el MP en pacientes con C-ARDS moderado/grave.
Materiales y método: Se realizó un estudio de cohorte prospectivo
incluyendo adultos con C-ARDS que requirieran DP. El protocolo fue aprobado por
un comité local (código 11/2020). Se recolectaron variables para el cálculo del
MP (convencional, ajustado a compliance MP-Csr y ajustado a peso predicho
MP-PCP): 1- En supino (SUP), 2- Quince minutos luego del DP (DP-1) manteniendo
programación ventilatoria; 3- De 2-4 horas luego del DP (DP-2). Además, se
obtuvieron gases en sangre arterial en SUP y DP-2. Se realizó un análisis post
hoc de diez sujetos contaron con monitoreo avanzado al momento de la inclusión
al estudio. Las variables numéricas se expresan como media (desvió estándar) o
mediana (cuartilo 1-3) según corresponda. Las categóricas como número (%). Para
la comparación entre condiciones se utilizó el test de Friedman. Se asignó
significancia a un valor de p<0.05.
Resultados: Incluimos 70 C-ARDS. El DP no indujo cambios
significativos en ninguna de las variantes de MP inmediatamente ni después de
2-4hs de haber asumido DP (Figura 1). La PaO2/FiO2 aumentó significativamente
con el DP (media de cambio (IC 95%): +36%(26-46); Wilcoxon - P<0,0001). En
diez sujetos que contaron con manometría esofágica se identificó que el
comportamiento de la ECT afecta el monitoreo del MP(Figura 2).
Conclusión: El DP no reduce el MP a corto plazo en
C-ARDS. El comportamiento de la ECT influye sobre el MP pudiendo afectar su
capacidad para evidenciar la respuesta al DP.
Figura 1. Mechanical power (MP), MP
normalizado a compliance del sistema respiratorio (MP-Csr) y MP normalizado a
peso corporal predicho (MP-PCP) durante posición supina (SUP), decúbito prono
inmediato (DP-1) y decúbito prono mediato (DP-2). Los datos son expresados como
mediana (Q1-Q3).
Figura 2. Panel superior: delta de presión en
la vía aérea, transpulmonar y esofágica en decúbito supino y prono al
estratificar los pacientes en los que mejoran la elastancia de la caja torácica
(ECT) (panel superior- izquierdo) y los que la empeoran (panel- superior
derecho). Panel inferior: media de mechanical power de la vía aérea en decúbito
supine y prono en los pacientes en los que mejoran la elastancia de la caja
torácica (ECT) (panel superior- izquierdo) y los que la empeoran (panel-
superior derecho).


LC Martinez Rigo(1),
M Enriquez Gentile(1), C Mena(1), A Bottaro(1), P Medici(1), M Nogueira(1), JE
Gonzalez Rapana(1), D Jauregui(1), D Natta(1), R Diaz(1), J Aranda(1), G
Navarro(1), Carr
(1) Hospital Interzonal Especializado Victorio
Tetamanti Mar Del Plata.
Durante la época invernal, existe gran
incidencia de enfermedad respiratoria provocada por virus Influenza, que
generalmente afecta el tracto respiratorio, con un amplio espectro de gravedad.
Si bien mayormente el virus de Influenza A causa cuadros autolimitados de vías
respiratorias, algunas de las presentaciones atípicas o complicaciones extra
respiratorias son : afectación muscular, renal, neurológica, cardiológica y de
las serosas, entre otras.
Se presenta a continuación un paciente con
poliserositis y taponamiento cardiaco, en el cual el rescate virológico fue
positivo para Influenza A.
Paciente masculino de 4 años, sin factores de
riesgo, con cuadro clínico de 5 días de evolución de dolor abdominal y fiebre,
que se interna por persistencia de sintomatología.
Durante su internación presenta desmejoría
clínica agregando palidez generalizada e hipotensión, asociados a sudoración,
taquicardia y disnea. Se constata ecográficamente derrame pericárdico severo
con signos de taponamiento cardíaco, derrame pleural bilateral y ascitis
moderada.
Se realiza pericardiocentesis, ingresando a
Unidad de Terapia Intensiva Pediátrica, con requerimiento de Asistencia
Respiratoria Mecánica y drogas vasoactivas.
Recibió antibioticoterapia empírica, sin
rescate etiológico bacteriano. La PCR fue positiva para el virus Influenza A en
secreciones nasofaríngeas y líquido pericárdico. Se descartaron otras
etiologías no infecciosas.
La evolución resultó favorable.
Por lo general, la poliserositis con pericarditis
aguda viral es autolimitada y responde bien a la administración de AINEs y
tratamiento de sostén, sobre todo para prevención de recurrencias. La terapia
con corticoides, de acuerdo a las diferentes citas bibliográficas, está
discutida, ya que podría reactivar las infecciones virales y hacer que la
inflamación persista. Nuestro paciente recibió tratamientos con AINEs y
corticoides, con buena evolución posterior.
El virus influenza genera con mayor
frecuencia una enfermedad respiratoria autolimitada, pero pueden ocurrir
complicaciones o formas de presentación con compromiso de serosas como
pericarditis que pueden conducir a taponamiento cardiaco y shock. Debe
considerar la afectación de serosas con pericarditis grave por virus influenza
A en pacientes de cualquier edad que presenten dolor torácico, taquicardia que
evolucionan con inestabilidad hemodinámica.
0278 Lesión renal aguda en
niños cursando postoperatorio de cirugía cardiovascular
M Sanz(1), P
Reyes(1)
(1) Universitario Austral.
La lesión renal aguda (LRA) es una
complicación frecuente que se presenta en el postoperatorio de cirugía
cardiovascular (CCV), con una incidencia del 30% al 40%; llegando hasta un 54%
- 64% en pacientes neonatales. El objetivo del presente trabajo es determinar
la incidencia de lesión renal aguda, de acuerdo los criterios de KDIGO, en
pacientes menores de 16 años, cursando postoperatorio de cirugía cardiovascular
e identificar factores de riesgo asociados a ella.
Se realizó un trabajo retrospectivo de la
incidencia de LRA en los pacientes cursando postoperatorio de cirugía
cardiovascular admitidos a la Unidad de Cuidados Intensivos Pediátricos del
Hospital Universitario Austral (HUA).
La incidencia de Lesión Renal Aguda (criterios
KDIGO) fue del 34,7% (n 17). El 29.4% de los pacientes con LRA (n 5) requirió
terapia de reemplazo renal (2 diálisis peritoneal y 3 hemodiálisis). 4 (23.6%)
de estos pacientes ingresaron a UCIP en ECMO. Del total de pacientes de la
muestra fallecieron 5 (10,2%). Dentro del grupo que presentó LRA fallecieron 4
correspondiendo al 23,6% de estos pacientes; en cambio dentro del grupo que no
presento LRA falleció 1 solo paciente (3,1%).
Los factores de riesgo evaluados para
desarrollar LRA se describen en la Tabla 2. Se pudieron asociar las siguientes
variables: Tiempo de clampeo aórtico > 100 minutos, OR: 3.28 (IC95%
1,66-9.65); Drogas vasoactivas mayor a 0.3 mcg/kg/min, OR: 2.1 (IC 95%
1.23-14.32) y Edad < 24 meses, OR: 3,69 (IC 95% 1.071-6.32).
Conclusión: En el presente trabajo la edad menor de 24
meses; el tiempo de clampeo aórtico > 100 minutos y la utilización de
catecolaminas a dosis mayor de 0.3 mcg/kg/min se asociaron con riesgo de
desarrollar LRA.
Tabla 1. Características de la población

Tabla 2. Factores de riesgo

0279 CARACTERISTICAS CLINICAS Y
MORTALIDAD DE PACIENTES CON COVID-19 GRAVES Y CRITICOS
E Cunto(1), V
Chediack(1), P Saul(1), A Rodríguez(1), R Gregori-sabelli(1), C Dominguez(1),
ME Artigas(1), Y Lamberto(1), M Flores Montes(1), I Prieto(1), JM Fernández(1),
MI Calderón(1), N Chacón(1), E Lista(1), L De Vedia(1)
(1) Muñiz.
Introducción: La mayoría de los pacientes afectados por
SARS-CoV-2, desarrollan síntomas leves a moderados, pero el 5% evolucionara a
insuficiencia respiratoria grave y requerirán ingresar en la unidad de cuidados
intensivos, con alto riesgo de morbilidad y altas tasas de mortalidad.
Objetivo: Determinar las características clínicas y
mortalidad de pacientes con COVID-19 graves y críticos.
Materiales y método: Estudio observacional, descriptivo,
retrospectivo. Periodo: marzo 2020-julio 2022. Pacientes ≥ de 18 años
ingresados en cuidados intensivos (CI). El diagnóstico de COVID-19 fue
realizado por clínica, imágenes y reacción en cadena de la polimerasa. Se usó scores APACHE II (Acute Physiology And
Chronic Health Evaluation II) y SOFA (Sepsis related Organ Failure Assessment).
Se utilizó Excel,
se realizó estadística descriptiva y test de Fisher para la comparación y p con
significancia estadistica ≤0.05.
Resultados: Pacientes ingresados en CI 2229: COVID
positivos (COV+) 1039 y COVID negativos (COV-) 1190.
Media de estadía en CI: COV+ 8,8 ±4,62 días.
Mujeres con COV+ 32%. Edad media COV+ 55
±7,79 años.
Coinfecciones asociadas a COV+ fueron HIV 90
pacientes (Incidencia 0,086) y tuberculosis (TB) 17 pacientes (incidencia
0,016. Mortalidad 75%). 6 pacientes COV+ con TBC y sida tuvieron 100% de
mortalidad.
Las comorbilidades más frecuentes asociadas:
hipertensión arterial 36% y diabetes 14%.
Media de APACHE II 16,7 puntos y SOFA 5
puntos.
En 2º y 3º ola de pandemia, 78 pacientes COV+
tuvieron insuficiencia renal aguda (incidencia 0,075), se usó terapia de
reemplazo renal lenta en el 90%. Letalidad 75%
Requerimiento de VM COV+ 51,49%.
En tabla 1 se observa COV+ con aumento de VM
y letalidad durante 2020-2021, con p significativa.
Tratamiento en COV+ 100% antibióticos,96%
dexametasona y 83% vasopresores, pocos pacientes seleccionados recibieron
anticoagulantes.
Conclusión: La asociacion de TB, COV+ y sida tuvieron
peores resultados, ninguno sobrevivió.
Recomendamos en pacientes HIV con o sin COV,
descartar TB latente, pueden coexistir y ser difícil de diferenciar.
Sugerimos un control cercano de pacientes con
1 o más comorbilidades y/o coinfecciones en el contexto de una sindemia.
Nuestra casuística evidenció elevado
requerimiento de VM y más letalidad en COV+ en el 2021 vs 2020. Esto lleva a
mayor uso de insumos, produciendo agotamiento de los recursos, especialmente en
el personal de salud.

0280 ENCEFALITIS HERPETICA CON
TRANSFORMACION HEMORRAGICA: UNA COMPLICACION MUY POCO FRECUENTE
L Tumino(1), E
Valgolio(1), MC Marchena(1), B Franco, I Zoilo, LE Baldaseroni, L Gatti, O Rolon,
S Eiguren, P Lucero, G Rolandelli, A Veitia, M Quiroga, M Girves
(1) Clinica San Camilo.
Introducción: La encefalitis herpética es la causa más
frecuente de encefalitis viral. El diagnóstico se realiza por la clínica,
imágenes y PCR en LCR. La Hemorragia intraparenquimatosa (HIP)es una
complicación muy poco frecuente, habiéndose reportado poco más de 27 casos al
2017.
Caso clínico: paciente de 77 años con antecedentes de
remplazo valvular aórtico y cardiopatía isquémica. Consulta por fiebre, caída
de propia altura y, posteriormente, convulsiones tónico-clónicas generalizadas
requiriendo intubación orotraqueal. RM: hiperintensidad temporal derecha con
edema vasogénico(fig.1). PL: pleocitosis mononuclear y proteinorraquia. PCR en
LCR positiva para VHS1. Sin recuperación neurológica, se realiza TC al 10mo
día: HIP fronto-temporal izquierdo con volcado ventricular y signos de
hipertensión endocraneana (HTE). Evacuación quirúrgica y polectomía temporal
(fig.2 y 3). Cumplió 21 días de Aciclovir. Externado tras 35 días con GOSE 3. A
los 6 meses del alta GOSE 4/5.
Discusión: Es muy infrecuente la complicación con un HIP
en el área afectada por la encefalitis, pese a verse microsangrados durante la
evolución, con una mortalidad del 5,2%. Si presenta HTE, se trata con
osmoterapia, sedantes e incluso barbitúricos y craniectomía descompresiva. No
se ha evidenciado diferencias entre el tratamiento médico y quirúrgico.
Conclusión: Cualquier empeoramiento de los síntomas
iniciales o manifestación de nuevos déficits neurológicos a pesar del
tratamiento antiviral adecuado, especialmente durante la segunda semana de
ingreso, justifica un estudio de neuroimagen, debiendo descartarse el
agravamiento del edema cerebral y la formación de un HIP.



0281 CRIPTOCOCOSIS MENINGEA POR
CRYPTOCOCCUS NEOFORMANS EN PACIENTE INMUNOCOMPETENTE
Y Lamberto(1), N
Grecco(1), C Dominguez(1), R Gregori-sabelli(1), P Saul(1), N Chacon(1), C
Susana(1), F Messina(1), L Gonzalez(1), MDLM Nano(1), P Velezquez Lopez(1), E
Cortez(1), V Chediack(1), E Cunto(1)
(1) Muñiz.
Introducción: La criptococosis meníngea es una infección
fúngica invasiva debida a Cryptococcus neoformans o en menor frecuencia a Cryptococcus
gattii, Presentan mayor prevalencia inmunosuprimidos, especialmente VIH,
trasplantados, entre otros. Presentamos una paciente inmunocompetente con
meningitis por Cryptococcus neoformans. Se discutirá la clínica, antecedentes,
posibles factores predisponentes, tratamiento y evolución.
Resumen clínico: Mujer de 17 años. Antecedentes de tuberculosis
pulmonar con tratamiento completo, desnutrición (39,500 kg, 152 cm, IMC 17),
progenitores con antecedentes de tuberculosis. Ingresa a terapia intensiva por
cefalea intensa de un mes de evolución, convulsiones, Glasgow 10/15. Tomografía
axial computada de cerebro normal, punción lumbar con presión de apertura de 50
cmH20,liquido cefalorraquídeo(LCR), límpido,incoloro, glucorraquia 27 mg/dl,
proteinorraquia 1.51 g/dl, 122 cel/mm, monomorfos (84%)Gram negativo, BAAR y
tinta china negativos. Se interpreta como posible meningitis tuberculosa inicia
ceftriaxona 4gr, isoniacida 300 mg, rifampicina 600 mg, etambutol 1200 mg,
pirazinamida 1250 mg diario. Al quinto día se obtiene cultivo de Cryptococcus
neoformans en LCR, antigenorraquia 1/1000, se rota a Anfotericina B liposomal +
Fluconazol. VIH negativa, hipocomplementemia C3 68 mg/dl (VN: 88-201mg/dl).
Cultivos de esputo, sangre y LCR bacteriológicos, micobacterias negativos.
Evoluciona con mejoría neurológica. Cumplió tratamiento de inducción. Externada
tres meses posteriores continuando con fluconazol.
Discusión: La meningitis por Cryptococcus neoformanses
es rara en inmunocompetentes. En las presentaciones en paciente VIH negativo,
hasta un 30% no presentan factores de riesgo. La infección por tuberculosis
causa una alteración en la inmunidad celular y se reconoce como factor
predisponente para Cryptococcus. Asimismo, Cryptococcus inhibe la producción de
factor de necrosis tumoral alfa y predispone a la reactivación/infección por
tuberculosis. El bajo peso también podría actuar como factor de inmunosupresión
agregado.
Conclusión: Es importante incluir dentro de los
diagnósticos diferenciales en meningitis a LCR claro patógenos no tan
frecuentes, como el Cryptococcus neoformans y evaluar factores predisponentes,
en la paciente, la desnutrición, la tuberculosis previa y la
hipocomplementemia. Consideramos que la importancia de este reporte es recordar
esta patología y sospechar su diagnóstico tempranamente ante una clínica
compatible aun sin factores de riesgo claros.
J Vilca(1), T
Juhasz(1), C Loudet(1), F Iglesias(1), L Tumino(1), G Saenz(1), T Sahar(1), A
Ortiz(1), F Cornejo(1), F Alfonsin(1), ME Zmolnig(1)
(1) San Martin.
Introducción: Los pacientes con requerimiento de
ventilación mecánica invasiva (VMI) prolongada presentan riesgos de intercurrir
con lesiones traqueales. A partir de la incorporación de un neumonólogo
especializado en fibrobroncoscopía (FBC) intervencionista fue posible la
detección y tratamiento de diversas lesiones. El objetivo de este trabajo fue
describir el tipo de lesión de la vía aérea hallado y la opción terapéutica en
pacientes que presentaron algún fallo en el proceso de decanulación con
lesiones confirmadas por FBC.
Métodos: Estudio de Serie de casos realizada en una
UCI medica-quirúrgica de 20 camas durante 2021-2022. Se registraron las
características epidemiológicas, escores de severidad y evolución de los
pacientes. Asimismo, se registraron todas las fallas en el proceso de
decanulación, y los hallazgos en la fibrobroncoscopia. Se calcularon la
frecuencia de estas lesiones.
Resultados: Se registraron 12 pacientes con lesión de vía
aerea. En el 50% la traqueostomía fue percutánea.
En la Tabla 1 se presentan las
características de los pacientes y en la Tabla 2 la indicación de FBC y sus
hallazgos.
Se pudo registrar que 4 (33.31%) presentaron
al menos 1 extubación programada no exitosa, 6 (50%) extubaciones no
programadas y al menos 8 (66,67%) cambio de cánula traqueal.
De todas las lesiones halladas 5 requirieron
algún tipo de prótesis traqueal para su resolución respectiva, 2 pacientes
quedaron con cánula Bielsasky, 2 con cánula subglótica y 3 pacientes pudieron
decanularse sin complicaciones posterior a dilatación por FBC.
Conclusiones: Las lesiones más frecuentes fueron de tipo
estenosantes. La falta de tolerancia a tapón fonatorio fue la principal
manifestación que permitió sospechar la presencia de lesión de vía aérea. La
posibilidad de contar con un especialista en FBC intervencionista permitió una
evaluación directa y posibilidad de tratamiento previos a la decanulación. El
próximo paso será reforzar las medidas preventivas de estas lesiones y la
protocolización de evaluación con FBC precoz en pacientes de riesgo que podrían
beneficiarse de ello.


0283 EXPERIENCIA EN MALARIA
GRAVE CON TERAPIAS CONTINUAS EXTRACORPOREAS. REPORTE DE UN CASO
R Gregori
Sabelli(1), JM Fernandez(1), CV Dominguez(1), P Saul(1), N Chacon(1), Y
Lamberto(1), G Astudillo(1), A Bocassi(1), E Cortez(1), Y Huarachi(1), S
Caceres(1), V Fernandez Arbelllo(1), V Chediack(1), ER Cunto(1)
(1) Muñiz.
Introducción: La malaria grave complicada es producida
mayormente por Plasmodium Falciparum (FP). Se caracteriza por afección orgánica
y/o hiperparasitemia. El número creciente de viajes internacionales a áreas
endémicas de paludismo hacen posible que el intensivista pueda enfrentarse a
pacientes con malaria grave. El diagnóstico tardío y tratamiento inapropiado
tiene alta mortalidad.
Presentación del caso: Varón de 36 años que ingresa a la unidad de
terapia intensiva de un hospital de la Ciudad de Buenos Aires derivado de otra
institución con diagnóstico de paludismo. Procedencia: Nigeria. Presentó fiebre
continua de 1 semana de duración, agrega deterioro del ritmo diurético y dolor
abdominal. Al ingreso lúcido, taquicárdico, taquipneico, ictérico, oligúrico,
con hipertensión arterial y requerimiento de drogas titulables (nitroglicerina).
El frotis de sangre periférica evidenció FP con nivel de parasitemia mayor a
20%. Se realizó exanguinotransfusión (volumen 3.4 litros). Comienza tratamiento
con artesunato endovenoso. El examen de laboratorio evidencia parámetros de
insuficiencia renal y aumento de bilirrubina sérica. Evoluciona oligoanúrico y
obnubilado. Se decide inicio de terapia continua extracorpórea:
plasmafiltración acoplada con adsorción (CPFA) y posteriormente plasmaféresis
de alto intercambio. Se objetiva notable mejoría del estatus neurológico y en
el laboratorio descenso significativo de cifras de bilirrubina sérica (Tabla
1). Lúcido, con mejoría de la función renal y de fallos de órganos, alta día
20.
Discusión: Nuestro paciente presentó malaria grave según
definición de Organización Mundial de la Salud (OMS). Si bien no hay estudios
representativos que avalen la utilidad de las terapias continuas, en este
paciente se observó mejoría clínica, identificándose en características
bioquímicas de la sangre y oxigenación tisular, sin eventos adversos.
Conclusiones: En esta experiencia las terapias
extracorpóreas continuas y el recambio plasmático han sido beneficiosos
proporcionando rápido descenso de niveles tóxicos de bilirrubinemia permitiendo
tiempo necesario para la acción de los antimaláricos de acción rápida hasta
negativización de parasitemia. Es de destacar que se necesitan estudios
aleatorizados para afianzar más conclusiones al respecto.

0284 LINFOPENIA EN EL PACIENTE CRÍTICO CON Y SIN OBESIDAD
V Fernández
Abello(2), R Gregori Sabelli(1), V Fernandez Abello(1), P Saul(2), C
Dominguez(1), MB Della Paolera(1), Y Lamberto(1), M Abot(1), S Caceres(3), M
Galindo(3), N Chacon(1), M Noceto(1), MDLM Nano(1), V Chediack(1), E Cunto(1)
(1) F. J Muñiz. (2) F. J. Muñiz. (3) F J
Muñiz.
Introducción: El 85% de los pacientes críticos covid 19+
con neumonía grave presenta linfopenia. La disfunción endotelial, menor
cantidad de linfocitos y aumento de citoquinas proinflamatorias son factores
que se asocian a mayor gravedad y disfunción inmunológica.
Se ha observado en varios estudios que la
obesidad y la linfopenia podrían ser factores asociados a mala evolución en el
paciente crítico COVID-19.
Otros factores como diabetes mellitus (DBT) e
hipertensión arterial (HTA) se han vinculado a aumento de morbimortalidad.
Objetivos:
Primarios
Analizar linfopenia en obesos y no obesos
como predictor de progresión de COVID-19 en terapia intensiva requerimiento de
asistencia ventilatoria mecánica (AVM) y mortalidad.
Secundarios
Describir y comparar comorbilidades asociadas
en obesos y no obesos.
Materiales y método: Estudio observacional, descriptivo,
retrospectivo, caso-control. Se evaluaron 100 pacientes críticos COVID-19
(Marzo 2020/Agosto 2021) 50 presentaron BMI >o= 30 (obesidad) y 50
presentaron BMI Se clasificó: Linfopenia leve-moderada:1000-500 cel x mm3.
Linfopenia severa La estadística descriptiva
usó porcentaje (%), media (M), rango (mínimo-máximo).
Se evaluó la relación entre la presencia de
obesidad y linfopenia con progresión a AVM o mortalidad mediante prueba de chi
cuadrado. Se consideró significativo una p < 0,05, se evaluó odds ratio (OR)
e IC95%.
Resultados: Pacientes con obesidad N=50 mujeres 25
varones 25 Edad (M) 60 (24-86 años).
Pacientes sin obesidad N=50 mujeres 13
varones 37 Edad (M) 57.6 (23-93 años.
La progresión a AVM fue significativamente
mayor en pacientes con obesidad y linfopenia (93%) que en aquellos sin obesidad
con linfopenia (66,6%) OR: 5,6, IC95% (2,2-14,5), p< 0,01. La mortalidad fue
significativamente mayor en pacientes con obesidad y linfopenia (84%) que en
aquellos sin obesidad con linfopenia 48,7%: OR: 5,92 IC955( 1,8-19,2) p<
0,01
Conclusiones: Según nuestra experiencia el recuento
linfocitario podría contribuir junto a otros factores de riesgo a identificar y
clasificar de forma rápida a pacientes que requerirán cuidados críticos sobre
todo en aquellos con presencia de obesidad. La asociación de obesidad y
linfopenia podría ser un factor predictor importante de la progresión a AVM y
mortalidad en pacientes COVID 19 en terapia intensiva.


0285 TRAUMA LARÍNGEO EXTERNO
SCHAEFER-FUHRMAN GRADO V: A PROPÓSITO DE UN CASO
F Puzzo(1), S
Cagide(1), J Gómez(1), L Diaz Ballve(1)
(1) Hospital Cuenca Alta.
Introducción: El trauma laríngeo externo, es una lesión
aguda infrecuente (1/30.000). Su severidad se clasifica según la escala de
Schaefer-Fuhrman, siendo el grado V disrupción laringotraqueal completa. La
mortalidad asociada a este tipo de lesiones es de 80% en la escena del trauma.
No hemos encontrado reportes de casos favorables publicados a la fecha. Se
describe el tratamiento y evolución de una paciente con trauma laríngeo externo
Shaefer-Furman grado V.
Presentación del caso: Masculino 22 años, con antecedentes de psicosis, consumo de drogas
ilícitas y fumador. Encontrado con herida de arma blanca en el cuello.
Trasladado a un hospital de segundo nivel. Presentó lesión completa de
cartílago tiroides con apertura íntegra de laringe y faringe. Se colocó cánula
de traqueostomía en porción distal de laringe y se derivó al Hospital Cuenca
Alta Néstor Kirchner. Ingresó a quirófano, se realizó traqueostomía,
reconstrucción de senos piriformes y faringostoma. Ingresó a unidad de cuidados
intensivos con asistencia ventilatoria mecánica y se desvinculó a los 4 días.
Funcionalmente requiere asistencia en actividades de la vida diaria. En el
octavo día se realiza gastrostomía para nutrición. Día 11, se traslada a
cuidados intermedios y se solicita prótesis para reconstrucción laríngea.
Adquiere independencia funcional a los 15 días de rehabilitación. Al día 59, se
realiza sutura y reconstrucción de cartílago tiroideo y cierre completo de
laringe y faringe (sin necesidad de prótesis). En el día 71 tolera oclusión de
cánula de traqueostomía con protección de vía aérea, a las 48 horas cumple
criterios clínicos decanulación. Día 79 luego de fibrobroncoscopia y
videodeglución se decide decanulación sin complicaciones.
Discusión: Los tiempos e intervenciones iniciales están
asociados a la supervivencia. La falta de evidencia demoró el proceso de
decanulación, se recurrió a estudios complementarios para disminuir la
incertidumbre que un caso como este puede generar en el equipo tratante. Sin
embargo, no arrojaron resultados diferentes a la evaluación clínica.
Conclusión: Se describe un paciente con trauma laríngeo
externo Schaefer-Fuhrman Grado V, una lesión con una alta morbi-mortalidad con
resultados favorables.


0286 ENDOCARDITIS CON
HEMOCULTIVOS NEGATVOS, REPORTE DE UN CASO DE ENDOCARDITIS POR BARTONELLA SPP
E Artigas(1), MA
Flores Montes(1), C Molina(2), S Santillan(1), A Rodriguez(1), L De Vedia(1), E
Cunto(1)
(1) Htal Dr Prof Francisco J. Muñiz. (2) Htal
Argerich.
Introducción: La endocarditis infecciosa (EI) es una
enfermedad de baja incidencia que se asocia con elevada morbimortalidad. El
diagnostico se basa fundamental en la tipificación el germen que la provoca, lo
cual también orienta hacia las conductas a seguir y el pronóstico. En aquellos
casos en que los hemocultivos son negativos, es necesario intentar del
diagnóstico mediante pruebas especiales las cuales no se encuentran en todos
los hospitales.
Presentación de caso: Paciente de 52 años, HIV+ en TARV, carga
viral indetectable, hipertensa, habita un domicilio con servicios, convive con
un gato. Consulta por síndrome constitucional de 2 meses de evolución, asociado
a dolor lumbar, hematuria macroscópica, registros febriles diarios y sudoración
profusa.
Al examen físico, se evidencia soplo
sistólico en foco aórtico, sin signos de fallo de bomba, y puño percusión
lumbar positiva.
La TAC de tórax evidenció lesiones nodulares
bilaterales subpleurales. En el ecocardiograma transtorácico se vio válvula aórtica
bicúspide con estenosis severa, e imagen hiperecogénica de 11 x 9 mm, móvil,
adherida a comisura y válvula mitral calcificada con imagen que protruye a
TSVI. Se interpreta como EI mitro-aórtica y se inicia tratamiento empírico con
ceftriaxona/vancomicina. Los hemocultivos fueron negativos.
Se solicita PCR para gérmenes no
convencionales, obteniéndose una PCR en sangre positiva para Bartonella spp,
por lo que se adecúa la antibioticoterapia a gentamicina/doxiciclina.
La búsqueda de impactos sépticos (fondo de
ojo, ecografía de abdomen y renal) no mostró hallazgos patológicos. Por buena
evolución clínica se decide egreso hospitalario y seguimiento por consultorios
externos.
Conclusión: La EI con
hemocultivos negativos es una enfermedad de difícil diagnóstico, que requiere
un enfoque multidisciplinario, y un tratamiento complejo que varía en cada
episodio. En todos los casos de endocarditis con cultivo negativo es primordial
una evaluación de factores epidemiológicos, antecedente de infecciones previas,
procedimientos invasivos, exposición a antimicrobianos, presentación clínica,
buscar focos de infección activos e intentar descartar causas no
infectológicas. Bartonella spp., es una zoonosis emergente que en pacientes
inmunocompetentes se asocia a la enfermedad de arañazo de gato y en los
inmunodeprimidos a enfermedades oportunistas mas invasivas por presentar
bacteriemias persistentes.
0288 ABSCESO CEREBRAL CON
RUPTURA HACIA SISTEMA VENTRICULAR POR Streptococcus intermedius
VD Toledo(1), M Montenegro(1),
A Violo(1), AC Di Nuzzo(1), A Ojeda(1), R Lobo(1), J Sereno(1), M Centurion(1),
F Alsina(1), E Mikulic(1)
(1) Hospital Militar Central.
Introducción: El absceso cerebral con ruptura hacia el
sistema ventricular es una complicación grave, poco frecuente y representa una
mortalidad superior al 80%. Se presenta caso de absceso cerebral con ruptura
hacia sistema ventricular en una paciente inmunocompetente.
Presentación: Paciente femenina de 63 años con antecedentes
médicos de obesidad, HTA y stent en vena cava superior por sarcoidosis
mediastinal. Ingresa a guardia médica por cefalea intensa y repentina con
vómitos asociados. En RNM de cerebro presenta lesión frontal derecha definida,
leve efecto de masa y realce en anillo al contraste ev (Foto 1 y 2). Se realiza
punción lumbar con muestra turbia y físico-químico de características
infecciosas. Interpretándose patología como absceso cerebral complicado con
ruptura hacia sistema ventricular. Se interna en UTI evolucionando con
deterioro del sensorio, requiriendo IOT y derivación ventricular externa con
abundante débito purulento. Inicia tratamiento antibiótico empírico con
Ceftriaxona y Ampicilina. A las 48 horas, se realiza drenaje de absceso y
lavado ventricular, continuando con DVE. Se obtiene rescate microbiológico de
Streptococcus intermedius multi sensible en LCR y muestra quirúrgica,
continuando con mismo esquema de tratamiento antibiótico, con mejoría clínica e
imagenológica. Curso internación prolongada con AVM y realización traqueostomía,
complicada con NAVM y recambio de stent por síndrome de vena cava superior.
Discusión: Se trata del caso de un absceso cerebral con
ruptura hacia el sistema ventricular por Streptococcus intermedius. Sin foco
aparente. Se realizó tratamiento agresivo con colocación DVE, antibiótico de
amplio espectro, drenaje y lavado quirúrgico. Continuando su seguimiento con TC
cerebro y buena evolución a los 20 días con retiro de DVE.
Conclusión: El absceso cerebral complicado con ruptura
hacia sistema ventricular constituye una patología poco frecuente en
inmunocompetentes y de alta mortalidad. Se presenta escasa bibliografía sobre
su tratamiento. Mediante estudios por imagen, muestras de cultivos,
antibioticoterapia y tratamiento quirúrgico precoz son decisivos en la
mortalidad de esta patología.


0289 PREDICCIÓN DE MORTALIDAD
EN NEUMONÍA GRAVE POR COVID 19 MEDIANTE ALGORITMO DE MACHINE LEARNING
A Antik(1), G
Genovese(1), MS Tomez(1), M Deguardia(1), R Ochoa(1), V Terrazas Cruz(1), AK
Marquez(1), I González Marquez(1), H Mamani Sánchez(1), MDLM Picos(1), F
Dana(1), M Izus(1)
(1) Durand.
Introducción: La neumonía por COVID 19 puede provocar
cuadros respiratorios graves con alta mortalidad. El uso de Machine Learning
(ML) podría constituir una herramienta adecuada para predecir la mortalidad en
estos pacientes.
Objetivo: Modelar algoritmos de ML para predecir la
mortalidad del paciente crítico con neumonía por COVID -19 con ARM invasiva.
Materiales y métodos: Se entrenaron y validaron los siguientes
algoritmos supervisados de clasificación de ML: Regresión Logística (RL), k
nearest-neighbors (KNN), support vector machines (SVM), Random Forrest (RF), y
Artificial neural network (ANN). Como variable de resultado se evaluó la
mortalidad, y como variables predictoras se incluyeron: edad, SOFA, ferritina,
PAFI de ingreso, y dímero D. Métricas de rendimiento: Accurancy y ROC. Lenguaje
de programación: Python. Bibliotecas: Pandas, Scikit-learn y Matplotlib. En
Ingeniería de datos se hicieron 4 cluster agrupando variables de laboratorio y
scores para mejorar la predicción. Estrategias de optimización de los
algoritmos: Random Search.
Resultados: Se incluyeron 212 pacientes con edad mediana
62 [Inercuartilar (IQ) 51-71], APACHE 15 [11-22], SOFA 7 [4-10], fallecidos
75%. Métricas de rendimiento en instancias de testeo fueron: RL y KNN,
presentaron igual resultado (Accurancy 0.78 ROC 0,71), SVM (Accurancy 0,78 ROC
0.61), RF (Accurancy 0,73 ROC 0,67] y ANN (Accurancy 0,77 ROC 0,78). Los
predictores de mayor impacto según el RL fueron: edad (coef 0,45) y SOFA (coef
0,33).
Conclusión: Los algoritmos entrenados presentaron similar
Accurancy, pero la ANN presentó mejor ROC. Si bien estos resultados son mejorables
con mayor número de instancias, y optimizando la ingeniería de datos, el ML
constituye una herramienta promisoria en la ayuda de toma de decisiones en
medicina. Este estudio proporciona una visión general con un rendimiento
aceptable de diferentes variantes de algoritmos de ML supervisado para la
predicción de mortalidad por neumonía por COVID grave.
CA Cimino(1), CF
Pereyra(1), E Martinez(1), J Kenny(1), V Aranda(1), M Willig(1)
(1) Trinidad De Ramos Mejía.
Introducción: La presentación neurológica no es infrecuente
en la endocarditis aguda. Incluso como puede presentarse como meningitis aguda,
introduciendo, de este modo, un importante sesgo diagnóstico.
Presentación de casos:
Caso 1
Mujer 83 años concurre por confusión,
disartria y registros febriles de 24 hs de evolución.
Antecedentes: Cirugía Carcinoma Basocelular.
Sobrepeso. Cataratas.
Estudios realizados: TC encéfalo y RMN
ingreso normales. PL inflamatoria. Cultivos: Hemocultivos 2/2 y Liquido
Cefalorraquideo con rescate Streptococcus Beta Hemolítico Grupo C (SBHC).
Cuarto día: hipoacusia, discromatopsia y
visión borrosa. Nueva RMN Focos isquémicos agudos bilaterales. Ecocardiograma
transtorácico (ETT) con Insuficiencia mitral leve. Ecocardiograma
transesofágico (ETE): Válvula mitral con masa móvil+regurgitación excéntrica
moderada: Endocarditis mitral nativa.
Caso 2
Varon 59 años concurre por confusión, trombocitopenia
y fallo renal.
Antecedentes: HTA, dislipemia, TVP, cáncer
basocelular, trombocitopenia en estudio, Implantes dentales.
Estudios realizados: TC encéfalo: Focos
puntiformes subcorticales frontal derecho. Punción lumbar LCR inflamatorio.
Hemocultivos 2/2 y LCR Staphylococcus aureus metic-S. RMN encéfalo: focos
isquémicos bilaterales agudos. ETT: no evidencia de imágenes patológicas. ETE:
Insuficiencia mitral moderada con dos vegetaciones de 21 mm. Endocarditis
mitral nativa.
Recambio valvular se difirió 45 días por
hemorragia cerebral aguda.
Caso 3
Varon 48 años concurre por fiebre, cefalea,
vomitos y confusión de 48 hs. Previamente Otitis media aguda.
Antecedentes: TVP bilateral. Hernioplastia.
Estudios. TC encéfalo: mastoiditis. Punción
lumbar LCR inflamatorio. Hemocultivos 2/2 y LCR Streptococcus pneumoniae. RMN
encéfalo: múltiples infartos isquémicos agudos bilaterales. ETT. Normal. ETE:
Válvula aórtica bicúspide Insuficiencia aórtica leve. Vegetación de 2x3 mm.
Endocarditis aórtica nativa.
Discusión: Las revisiones de meningitis aguda sugieren
tomografía computada para prevenir complicaciones de la punción lumbar. La RMN
estaría indicada cuando hay deterioro neurológico ulterior.
Sin embargo, una vez diagnosticada meningitis
aguda, el tratamiento antibiotico podría enmascarar o solapar los signos o
sintomas de endocarditis siendo, de este modo, subdiagnosticada. Los infartos
cerebrales que a posteriori pudieran aparecer podrían atribuirse a meningitis
de forma errónea.
La endocarditis podría ser entonces
subdiagnosticada con consecuencias indeseables como duración del tratamiento
inadecuada.
La RMN precoz con patente de infartos agudos
embólicos agudos ayudó a romper este sesgo diagnóstico.
Conclusión: La RMN al inicio del síndrome meníngeo podria
ayudar a detectar mas cuadros de endocarditis por incluirla dentro de los
diagnósticos diferenciales.


0293 PATOLOGÍA POR CONSUMO DE
CONSERVAS: BOTULISMO EN EL NOA, REPORTE DE CASOS
AM Sanchez(1), AN
Vides(1), N Saragusti(1), N Llanes(1), R Retambay(1), MC Sotelo(1), M
Corona(1), J Maidana(1), R Reinoso(1)
(1) San Bernardo.
Introducción: El botulismo alimentario es una intoxicación
grave, potencialmente fatal, tratable y prevenible; producida por la ingestión
de una neurotoxina (clostridum botulinum). Enfermedad poco frecuente, en
nuestro país se registran anualmente 25-30 casos, por lo cual requiere un alto
índice de sospecha para el diagnóstico precoz y el tratamiento oportuno.
Presentación del caso: Se presenta el caso de dos hermanos varones
de 23 años (caso 1) y 24 años (caso 2), de profesión pescadores, sin
antecedentes patológicos de relevancia, que ingresan por guardia derivados de
hospital del interior de la provincia, 24hs posteriores a la ingesta de
escabeche de pescado de elaboración artesanal.
Caso 1: 24hs de dolor abdominal, vómitos,
sensación febril, y cefalea occipital con somnolencia.
Examen físico: hipotonía muscular
generalizada fuerza muscular 2 ⁄ 5 en 4 miembros, Glasgow 9/15 (RO2,RM5,RV2),
pupilas isocóricas. Signos clínicos de fallo ventilatorio inminente,
normotension y taquicardia.
Insuficiencia respiratoria hipercápnica, se
decide intubación y vinculación a ARM.
Laboratorio: GB:10600, Hto 54%, Gasometría:
pH 7.19 PO2 73, HCO3 25, PCO2 69.
Punción lumbar: normal. TC sin alteraciones
relevantes.
Caso 2: dolor abdominal difuso y vómitos de
12hs de evolución, diplopía, disminución de agudeza visual. Al examen físico:
Glasgow 15/15, parálisis de 6to par izquierdo y retracción palpebral, sequedad
ocular, lúcido, sin déficit motor ni sensitivo.
Exámenes complementarios sin alteraciones.
Intubación precoz.
Se interpreta como intoxicación por toxina de
clostridium botulinum, se solicita serología, se administra antitoxina
botulínica bivalente A y B.
Evolución en UTI: ARM prolongada,
recuperación completa a la fecha.
Discusión: La pentada clásica de síntomas y signos de
botulismo incluyen sequedad de boca, náuseas/vómitos, disfagia, diplopía y
midriasis paralítica, el 13% de los pacientes presenta pentada completa, el 90%
una triada. La sospecha clínica es esencial, aunque hay diagnósticos
diferenciales, no existe una entidad similar donde se combine la afectación de
musculatura estriada y lisa.
Conclusión: La difusión de este tipo de casos es
relevante porque se presentan con sintomatología clásica de botulismo, siendo
este subdiagnoticado por su baja incidencia, y en el cual tratamiento oportuno
mejora el pronóstico.
0294 COMUNICACIÓN INTERVENTRICULAR
MULTIPLE, COMPLICACION GRAVE Y POCO FRECUENTE POST INFARTO
S Gasparotti, LM
Rodriguez(1), FP Bertoletti
(1) Clínica San Jorge.
Introducción: La Comunicación Interventricular (CIV) es una
complicación infrecuente del Infarto Agudo de Miocardio (IAM), con una
incidencia en la era pre-trombotica del 1-2% al 0.2% en la era trombolítica.
Con índice de mortalidad elevado (superior al 80%).
La cirugía cuando debe practicarse de manera
temprana, conlleva una elevada mortalidad e incidencia de defectos residuales
superior al 40%.
Presentación del caso: Paciente de 54 años, curso internación por
Infarto Agudo de Miocardio Anteroseptal Extenso, con CCG con ateromatosis
severa de arteria coronaria izquierda, Descendente Anterior, Circunfleja y Rama
Lateral Alta; Angioplastia Coronaria Fallida. Evoluciona con shock
cardiogenico, comunicación interventricular y Neumonía Intrahospitalaria.
Falla multiorganica. Se realiza CRM y cierre
de CIV. Recidiva de CIV en sitio de anclaje del parche, con reintervención y
cierre y persistencia en punta del Septum con imposibilidad técnica/anatómica
de cierre. Por vía endoscópica se realiza cierre definitivo con dispositivo
tipo Amplatzel. Por ETE se constata Jet comunicante residual apical. Evoluciona
favorable.
Discusión: Las complicaciones de un IAM, pueden ser no
mecánicas y mecánicas. Las CIV es un evento con una alta tasa de mortalidad
intra-hospitalaria. Aparece entre los 3-5 días de inicio de los síntomas. La
clínica incluye ángor, disnea, insuficiencia cardíaca izquierda o shock
cardiogénico. Soplo holosistólico y frémito palpable. R3 y R2 pulmonar
acentuado debido a hipertensión pulmonar.
El diagnóstico se hace por ecocardiografía,
que valora tamaño del defecto, la función y las presiones ventriculares y el
shunt.
El manejo inicial con terapia médica, permite
estabilizar al enfermo y realizar la corrección quirúrgica/endoscópica
percutánea.
El tiempo de espera promedio era de tres a
seis semanas para permitir la cicatrización de los bordes del tejido necrótico
y facilitar así el procedimiento quirúrgico.
Conclusión: La CIV es una complicación infrecuente de los
IAM, con alta mortalidad. Ante síntomas clínicos y hallazgos semiológicos debe
sospecharse para iniciar el tratamiento médico correspondiente que permita
realizar la reparación correspondiente.
C Gomez(1), A
Peralta(1), A Urquhart(1), F Fretes(1), T Scholtz(1), N Galeano(1), P Rolon(1),
H Bianco(1), F Ferreira(1), B Figueredo(1)
(1) Hospital De Clínicas.
Introducción: Los pacientes con enfermedad renal crónica,
particularmente aquellos en etapa dialítica, requieren hospitalizaciones y
cuidados críticos en mayor proporción que la población general, y presentan
características particulares tanto fisiopatológicas como pronósticas, que son
además diferentes a la de los pacientes dializados por insuficiencia renal
aguda.
Objetivo: Determinar la mortalidad en pacientes con
enfermedad renal crónica en terapia dialítica (ERCD) en el Departamento de
Cuidados Intensivos de Adultos del Hospital de Clínicas desde enero de 2016 a
agosto de 2020, y describir sus características demográficas y clínicas.
Materiales y Método: Estudio observacional, descriptivo, de corte
transversal, retrospectivo. Los sujetos fueron pacientes con ERCD internados en
nuestro departamento, cuyos datos fueron obtenidos de las historias clínicas.
Las variables estudiadas fueron edad, sexo, comorbilidades, diagnósticos de
ingreso, tipo de acceso vascular, scores de gravedad: APACHE II y SOFA al
ingreso, requerimiento de ventilación mecánica, días de internación, y la
mortalidad.
Resultados: Se incluyeron 149 pacientes. Mediana de edad
51±15 años, 51% eran mujeres. Las comorbilidades más comunes fueron
hipertensión arterial 39,6%(59), diabetes mellitus 12,8%(19) y colagenopatías
8,1%(12). Los diagnostico de ingreso más frecuentes fueron sepsis/shock séptico
36,9% (55), postoperatorio inmediato 19,5% (29), insuficiencia respiratoria
17,4% (26). Recibieron hemodiálisis intermitente por catéter simple 67% (100),
fistula arteriovenosa 26% (40) y catéter tunelizado 6% (9). La mediana APACHE
II 23,7±8,42, SOFA al ingresofue9,76±3,48. Necesitaron ventilación mecánica el
74% (110), con promedio de días en ventilador de 5,43 ±7,11. Mediana de días de
internación en cuidados intensivos fue 8,7±7,7 y la mortalidad fue 34,23% (51)
Conclusión: La mortalidad en nuestros pacientes fue
elevada con respecto a lo reportada en la literatura internacional con puntajes
altos en los scores de severidad.
J Quiroz Cedeño(1),
G Monti(1), G Gaudenzi(1), P Verta(1), M Rolando(1), K Banzer(1), O
Ferrufino(1), M Mansur(1), F Perez(1), D Parraga(1), K Gamarra(1), A
Canchila(1), A Fernandez(1), A Gonzalez(1), D Mingoni(1)
(1) Central San Isidro.
Introducción: La miocardiopatía séptica fue descrita como
una disminución de la fracción de eyección ventricular izquierda desde 1984 por
Parker; desde entonces se han señalado un conjunto de mecanismos
fisiopatológicos causantes, asociados a un estado inflamatorio sistémico donde
intervienen interleucinas, TNF y fallo contráctil de miocitos. Se caracteriza,
además, por ser una enfermedad transitoria, con resolución entre los 7 a 10
días. La importancia de conocer esta patología radica en su complejo diagnóstico,
pronóstico y adecuado tratamiento.
Presentación de caso: Paciente masculino de 50 años de edad, con
antecedentes de TVP femoral izquierda. Ingresa el 25/12/2021 a otro sanatorio por
Insuficiencia respiratoria secundaria a probable TEP, quien requirió intubación
endotraqueal por 6 días, con intercurrencias infectológicas, se logra extubar.
El 04/01/2022 es derivado a
nuestro Hospital con falla ventilatoria y oxigenoterapia suplementaria. El
07/01/2022 se realiza Ecocardiograma sin signos de TEP, sin HTP, FEVI de 65%, (Fig.1). Con mala
evolución requerimiento de ARM, se realizan policultivos y PCR para Covid 19
siendo positivo, además se documenta SAMR en muestra respiratoria. Se realiza
TAC de tórax que evidencia consolidaciones bibasales (Fig. 2), evoluciona con
shock séptico refractario, el 14/01/2022 se realiza nuevo ecocardiograma con
FEVI estimada de 30% (Fig.3) por lo que se inicia manejo hemodinámico bajo guía
ecográfica, con mejoría progresiva, finalizando tratamiento antibiótico durante 10 días. El
16/02/22 se realiza Ecocardiograma con FEVI 62%. Alta hospitalaria a los 51
días de hospitalización.
Discusión: La miocardiopatía séptica cada vez cobra más
importancia debido al aumento de su incidencia, probablemente por ser
subdiagnosticado al pensar que los pacientes tenían un gasto cardíaco alto. En
la actualidad gracias al incremento del uso y formación en ecografía crítica,
se ha logrado diagnosticar y tratar precozmente.
Conclusión: No es una entidad infrecuente, su forma más
común es la disfunción miocárdica sistólica del ventrículo izquierdo, se
relaciona con peor pronóstico y en los supervivientes, la FEVI se normalizó
tras la recuperación del evento agudo.


I Gavilan(1), J
Figueredo(1), C Figueredo(1), L Fontclara(1), AM Ferreira(1), N Crosta(1), LM
Pederzani(1), H Bianco(1), F Ferreira(1), B Figueredo(1)
(1) Hospital De Clínicas.
Introducción. El SARS-CoV-2 desde el 2020 generó
innumerables desafíos. El decúbito prono se utilizó para mejorar la
oxigenación, y la terapia nutricional se adaptó para cubrir los requerimientos
y reducir complicaciones.
Objetivos: Evaluar la tolerancia de la nutrición enteral
en pacientes ventilados en decúbito prono con infección de SARS-CoV-2, en sala
respiratoria del Departamento de Cuidados Intensivos Adultos del Hospital de
Clínicas-Facultad de Ciencias Médicas -Universidad Nacional de Asunción, de
marzo a julio 2021.
Materiales y Métodos: Estudio transversal,
descriptivo-retrospectivo, datos recabados de fichas de pacientes de la sala
respiratoria, que recibieron soporte nutricional en posición supina y prona. Se
evaluó la tolerancia de la nutrición durante la posición prona, definiéndola
como presencia de residuo menor de 500 ml c/6hs. Se tuvo en cuenta datos
demográficos, clínicos y nutricionales (aporte calórico, adecuación energética,
tipos de fórmulas). La adecuación calórica fue estimada según el requerimiento
y la prescripción en comparación con el aporte administrado
Resultados: Se reclutaron 41 pacientes. El 60,9% de los
pacientes eran hombres; el promedio de edad fue 55 años. Las principales
comorbilidades fueron obesidad (57,3%) e hipertensión arterial (43,9%). El 100%
de los pacientes requirió al menos en una oportunidad adoptar la posición prona
durante la internación. El óbito se dio en el 48,8% de los pacientes
internados. El 68,3% presentó bajo riesgo nutricional según el Nutric Score. Un
75,6% inicio la nutrición enteral dentro 24 a 48 h posterior al ingreso a la
unidad. El 82,9% no presentó intolerancia gástrica en posición prona ni supina,
un 2,6% presentó residuo gástrico > 500 ml durante todo el tiempo que
permaneció en posición prona, que fueron mínimo 2 hs y máximo 72 hs. La mediana
del aporte calórico fue de 2240±194,2 kcal/día. El porcentaje de adecuación
energética fue de 84%. En un 36,6% fueron indicadas fórmulas específicas.
Conclusión: La terapia nutricional enteral en decúbito
prono fue bien tolerada y segura en la mayoría de nuestros pacientes,
posibilitando alcanzar los requerimientos nutricionales indicados.
I Colman(1), J
Figueredo(1), F Fretes(1), L Fontclara(1), J Cabral(1), R Paez(1), R
Caballero(1), J Pereira(2), H Bianco(1), B Figueredo(1)
(1) Hospital De Clínicas. (2) Centro De
Especialidades Dermatológicas. Ministerio De Salud Y Bienestar Social.
Introducción: Las infecciones fúngicas pulmonares con
COVID-19 se reportan como complicación asociada a una alta mortalidad en
terapia intensiva. Además de los factores comunes para la infección por hongos,
tales como diabetes mellitus, infección por influenza, uso de antibióticos de
amplio espectro, entre otros, se ha sumado la utilización de corticoides y
tocilizumab en el tratamiento de los pacientes críticos con COVID-19. Existen
estudios publicados que mencionan un riesgo de adquirir aspergilosis pulmonar
tres veces mayor en pacientes COVID-19, con corticoterapia, antibióticos de
amplio espectro y estadía prolongada.
Se presenta una serie de casos, 7 pacientes
hospitalizados en el Departamento de Cuidados Intensivos Adultos del Hospital
de Clínicas en un período de marzo a julio del 2021
Casos Clínicos: Edad entre 43 – 67 años (4 de sexo
masculino), en la que se destaca como comorbilidad principal la diabetes y
obesidad. Todos ingresaron por dificultad respiratoria y fiebre, con un APACHE
II de 19±6 y SOFA INICIAL de 4±3.
En las tomografías axiales computarizadas de
tórax se evidenciaron áreas en vidrio esmerilado de distribución periférica
bilateral y en un caso, imagen cavitada de contenido sólido. Los hongos
aislados en el lavado bronquioalveolar fueron: Aspergillus (5 pacientes),
Geotrichium (1 paciente) y Mucormicosis (1 paciente). Los 7 recibieron
corticoides, 3 recibieron Tocilizumab y todos requirieron asistencia
respiratoria mecánica dentro de las primeras 48 horas. Se administró
Anfotericina B desoxicolato en 5 pacientes con aspergilosis, el paciente con
Mucormicosis recibió Anfotericina B liposomal y Voriconazol y uno falleció
precozmente, antes de conocerse el diagnóstico. La mediana de días de
internación fue 17±9. Presentaron desenlace fatal en cuidados intensivos 4 de
los pacientes.
Conclusión: Es el primer reporte de nuestro país sobre
pacientes críticos con COVID-19 complicados con infecciones fúngicas, las
subespecies encontradas son similares a las mencionadas por la literatura
internacional.


0299 REPORTE DE UN CASO.
SÍNDROME DE ABSCESO HEPÁTICO INVASOR POR KLEBSIELLA PNEUMONIAE
K Banzer(1), G
Monti(2), G Gaudenzi(2), C Llerena(2), J Quiroz(2), O Ferrufino(2), M Rolando(2),
M Mansur(2), F Perez(2), D Parraga(2), K Gamarra(2), A Canchila(2), A
Fernandez(2), A Gonzalez(2), D Mingoni(2)
(1) Hospital Central De San Isidro. (2)
Central San Isidro.
Introducción: Los abscesos hepáticos producidos por
klebsiella pneumoniae constituyen el síndrome de absceso hepático invasor. Esta
patología puede producirse aún en ausencia de enfermedad hepatobiliar o
colorrectal concomitante que pudiera facilitar el ascenso del microorganismo.
Presentación del caso: Paciente masculino de 66 años, FRCV ex
tabaquista. Consulta por fiebre y escalofríos de 24 horas de evolución, se
realiza TC de tórax sin infiltrados, TC de abdomen y pelvis sin contraste la
cual se informa esteatosis hepática difusa. En el laboratorio presentaba falla
de múltiples órganos. Luego de la toma de cultivos se inició empírico
Piperacilina Tazobactam más Vancomicina. La ecografía abdominal, informó
vesícula con barro biliar y litiasis múltiples, en hígado una imagen de
densidad heterogénea de 50 x 30 mm en segmento III. En hemocultivos se obtuvo
2/2 Klebsiella pneumoniae. Por sensibilidad se decide desescalar a
ampicilina-sulbactam. Se realizó drenaje percutáneo guiado por ecografía, con
rescate de K. pneumoniae. El paciente cumplió tratamiento antibiótico por 4
semanas posteriores al último drenaje, evolucionando favorablemente. Tras su
internación requirió traqueostomía percutánea, fue decanulado y externado.
Discusión: El síndrome de absceso hepático invasor por
K. pneumoniae se caracteriza por la aparición de un absceso primario hepático
con aislamiento monobacteriano, asociado en el 12% de los casos, a siembra
metastásica del patógeno. Las manifestaciones asociadas descriptas son
endoftalmitis, meningitis y absceso cerebral. Existen cepas virulentas que
tienen la capacidad de invadir un hígado sano sin producir alteraciones
estructurales. Sin embargo, no se puede excluir la posibilidad de enfermedad
colorrectal como medio de diseminaciòn, ya que la colonoscopia de rutina no se
realiza en el contexto de absceso primario por K. pneumoniae. Con respecto a
los factores de riesgo, se encuentran descriptos la diabetes mellitus y la
esteatosis hepática. La ecografía y la tomografía son los métodos para el
diagnóstico, y la punción guiada se considera útiles.
Conclusión: La letalidad reportada por el síndrome de
absceso hepático invasor es baja, las complicaciones a largo plazo, conllevan
una alta morbi-mortalidad. Es de fundamental importancia la sospecha clínica,
con el fin de lograr el diagnóstico temprano y un tratamiento oportuno.

0300 El músculo medido en la
tomografía de tórax no predice mortalidad en terapia intensiva
SP Chapela(1), SP
Chapela(2), M Aquino(2), MJ Reberendo(2), L Carmona Diaz(2), ND Llobera(2), C
Peñaranda(2), A Garcia(2)
(1) Hospital Britanico. (2) Hospital
Británico De Buenos Aires.
Introducción: La sarcopenia es una patología de alta
prevalencia en terapia intensiva. El gold estándar para el diagnóstico es la
tomografía de abdomen a nivel de la tercera vértebra lumbar. Sin embargo, el
traslado de los pacientes es complejo y no todos los pacientes requieren
tomografías de abdomen.
Objetivos: Determinar si la medición de músculo a nivel
de la doceava vértebra torácica sirve para predecir mortalidad en pacientes
internados en terapia intensiva con COVID-19.
Métodos: Se incluyeron pacientes en ventilación
mecánica con diagnóstico de COVID-19 a los que se les realizó tomografía de
tórax dentro de las primeras 48 horas de ingreso. Se midió con el programa
coreslicer el músculo y la grasa a nivel de la doceava vértebra dorsal. El
outcome fue mortalidad en UTI. Se calculó sensibilidad, especificidad y área
bajo la curva (AUC).
Resultados: Se reclutaron 51 pacientes. Las
características de la población se describen en la tabla 1. El músculo medido
por tomografía de tórax no predice mortalidad (AUC = 0.621; sensibilidad 38.89;
especificidad: 92.59; P=0.19) (Imagen 1A). La grasa medida por tomografía de
tórax no predice mortalidad (AUC = 0.595; sensibilidad 55.56; especificidad:
70.37; P = 0.3) (Imagen 1B).
Conclusión: La medición del músculo en la tomografía de
tórax no es una herramienta útil para predecir mortalidad.


0301 Calorimetría indirecta
según el tiempo de estadía en terapia intensiva
SP Chapela(1), MJ
Reberendo(2), F Gutierrez(2), AH Reque Panozo(2), ND Llobera(2), CA Navarro
Pabon(2), SP Chapela(2)
(1) Hospital Britanico. (2) Hospital
Británico De Buenos Aires.
Introducción: La calorimetría indirecta es el gold estándar
para la determinación del gasto calórico en reposo. El paciente crítico durante
su estadía en terapia intensiva sufre diversos cambios metabólicos. Estas
etapas se pueden dividir en fases Ebb y flow, y crítico crónicamente enfermo.
Objetivos:Determinar el gasto calórico en reposo de
pacientes en ventilaciòn mecànica en fase ebb (días 0-3), fase flow (4-14 dìas)
y crítico crónicamente enfermo (más de 14 dìas)
Métodos: Se incluyeron pacientes críticos en
ventilación mecánica a los que se les realizó calorimetría indirecta, de
acuerdo a indicación de los equipos tratantes. Se excluyeron a pacientes con
FIO2 inestable o mayor a 60%, fuga en el circuito, en diálisis hasta 2 horas
previas al estudio, o ventilación en decúbito prono. Se midieron a los
pacientes, registrándose la altura en cm, y se registró el peso de acuerdo a
datos aportados por los pacientes previo a la ventilación, por la familia o se
calculò al lado de la cama. Se calculó el peso ideal con la fórmula de Miller
[(varon = 50kg + 0.555 * (altura (cm) - 152.4) y (mujeres = 45.5kg + 0.535 *
(altura (cm -152.4)]. Se realizó test de ANOVA para detectar diferencias entre
las distintas etapas.
Resultados: Se reclutaron 55 pacientes. La descripción de
la población se realiza en la tabla 1. No hubo diferencias en el gasto calórico
en reposo entre las 3 etapas (P=0.12), tampoco hubo diferencias en el gasto
calórico ajustado al peso (P=0.7), ni en el gasto calórico ajustado al peso
ideal (P=0.14). Los datos se describen en la tabla 2.
Conclusión: En la población de pacientes en terapia
intensiva no hay diferencias en el gasto calórico en distintas etapas
metabólicas, pero esto no significa que no haya diferencias individuales. Se
necesitan más estudios al respecto.


0302 Calorimetría indirecta en
pacientes obesos en ventilación mecánica
SP Chapela(1), ND
Llobera(2), F Gutierrez(2), AH Reque Panozo(2), MJ Reberendo(2), CA Navarro
Pabon(2), SP Chapela(2)
(1) Hospital Britanico. (2) Hospital
Británico De Buenos Aires.
Introducción: Para la determinación del gasto calórico en
reposo, la calorimetría indirecta es el gold estándar. Cuando no se cuenta con
el equipo necesario, hay ecuaciones predictivas, pero ninguna muestra una buena
correlación con la calorimetría indirecta.
Objetivos: Determinar el gasto calórico en reposo de
pacientes obesos y comparar con pacientes con sobrepeso y peso normal.
Métodos: Se incluyeron pacientes críticos en ventilación
mecánica a los que se les realizó calorimetría indirecta, de acuerdo a indicación
de los equipos tratantes. Se excluyeron a pacientes con FIO2 inestable o mayor
a 60%, fuga en el circuito, en diálisis hasta 2 horas previas al estudio, o
ventilación en decúbito prono. Se midieron a los pacientes, registrándose la
altura en cm, y se registró el peso de acuerdo a datos aportados por los
pacientes previo a la ventilación, por la familia o se calculò al lado de la
cama. Se calculó el peso ideal con la fórmula de Miller [(varon = 50kg + 0.555
* (altura (cm) - 152.4) y (mujeres = 45.5kg + 0.535 * (altura (cm -152.4)]. Se
realizó test de ANOVA para detectar diferencias entre grupos.
Resultados: Se incluyeron
55 pacientes. La descripción de la población se detalla en la tabla 1. Se
observó que no hubo diferencias en el gasto calórico total (P=0.24), ni en el
gasto calórico ajustado al peso ideal (P=0.19). En cambio hubo diferencias
significativas al ajustar al peso actual (P=0.0047). Los datos se expresan en
la tabla 2.
Conclusiones: El cálculo del gasto calórico en reposo, al
ajustar por el peso actual difiere entre pacientes obesos y normopeso, pero no
hay diferencias al ajustar por peso ideal.


0304 SINDROME DE ONDINA ADQUIRIDO
REPORTE DE UN CASO
E Porjolovsky(1), EM
Porjolovsky(2), P Cordero(2), L Pero(2), D Lafosse(2), A Tristaino(2), N Perez
Murua(2), K Cisneros(2), B Castro(2), L Franconieri(2)
(1) Snatorio Antartida. (2) Sanatorio
Antartida.
Introducción: El síndrome de ondina, es una enfermedad
neurológica infrecuente, donde existe fracaso en el control de la ventilación
en el sistema nervioso central llevando a hipoxemia e hipercapnia. Generalmente
más frecuente en niños y de carácter congénito.
Presentación: Paciente femenina de 44 años de edad con
antecedentes de HTA. Ingresa derivada por presentar 96 hs previas paresia
facial derecha con diagnóstico de LOE en fosa posterior compatible con
meningioma que luego se confirmara por anatomía patológica.
Ingresa al servicio de terapia intensiva en
el post operatorio de craniectomía y exeresis de masa tumoral. Extubada,
lucida, sin déficit motor. Se realiza TC control: ventriculomegalia,
hipodensidad en fosa posterior compatible con huella quirúrgica y
neumoencefalo.
Durante la estadia en UTI 12 hs del post
operatorio intercurre con midriasis bilateral asociado a deterioro neurológico
y desaturación extrema con paro respiratorio requiriendo de asistencia
ventilatoria mecánica.
Se realiza nueva TC control inmediata sin
cambios. Posteriormente presenta buen intercambio gaseoso por lo que se
suspende sedación con weaning exitoso sin secuelas neurológicas. Se descarta
intoxicación por fármacos.
A las pocas horas post extubación la paciente
vuelve a intercurrir con apnea profunda y desaturación que requiere
ventilación. Se decide mantener en asistencia ventilatoria y se constata apnea
sin respuesta a hipoxemia ni hipercapnia. Se interpreta el cuadro como síndrome
de ondina adquirido.
Conclusión: Son pocos los casos documentados en la
bibliografía con diagnóstico de sme de ondina. La evolución es variada,
mostrando algunos pacientes mejoría de la ventilación espontanea con el tiempo
y otros requiriendo ventilación invasiva de por vida.


0305 VExUS: NUEVO SISTEMA DE
VALORACION VENOSA CON POCUS
AS Avila Vera(1), J
Bleis(2)
(1) Durand. (2) Elizalde.
Introducción: VExUS (venous excess ultrasound score) -
POCUS (point-of-care ultrasound)
El manejo hemodinámico del paciente crítico
se ha enfocado al mantenimiento de un adecuado gasto cardiaco con la
administración de fluidos, vasopresores.
Sin embargo, la perfusión de los diferentes
órganos se ve afectada por otros factores, la congestión venosa. Esto es
especialmente notable en pacientes con sobrecarga hídrica, insuficiencia
cardiaca o hipertensión pulmonar, si se produce una falla renal agrava la
congestión venosa.
Presentación del caso: paciente de 7 meses de edad, 1° día post
quirúrgico de tetralogía de Fallot con ampliación tronco y ramas pulmonares, en
ARM, soporte de inotrópico, e inodilatadores, requirio 2 expansiones y
Transfusión de Glóbulos Rojos manteniendo signos vitales Fc 145 x´ Ta 86/49 SO2
99% PVC 15 mmHg. Se realiza protocolo VExUS encontramos, Vena Cava Inferior sin
colapso, Suprahepatica con flujo Bifásico, Flujo de vena Porta pulsátil y venas
Renales pulsátiles, se concluye que el paciente se encuentra en VExUS severa
congestión, se procede a la desresucitación con goteo de diuréticos, logrando
balance negativo, Control a las 24. VExUS congestión moderada, mismo
tratamiento hasta lograr VExUS normal, extuba sin complicaciones.
Discusión: La ecografía POCUS permite realizar una
valoración funcional a pie de cama de la situación hemodinámica y en tiempo
real. Con la modalidad Doppler podemos evaluar el volumen y los factores
ligados a la congestión.
Conclusión: Remarcar la necesidad de más estudios para
validar el protocolo VExUS en diferentes contextos clínicos que confirmen los
criterios óptimos y determinen si se puede usar para individualizar el manejo
hemodinámico de la congestión venosa.


FE Kulik(1), VR
Giudicce(1), TC Navarro Toffaletti(1), VV Espindola(1), FN Falcon(1), ML
Braccini(1), AE Piacenza(1)
(1) Instituto De Cardiología De Corrientes
Juana Francisca Cabral.
Introducción: El retraso en la función del injerto (RFI)
definido como la necesidad de diálisis dentro de los siete días posteriores al
trasplante es una complicación frecuente, cuya aparición dificulta el manejo
del paciente trasplantado prolongando la estancia hospitalaria y aumento de los
costos.
Objetivo: Analizar los factores asociados a RFI
relacionados al donante y al receptor, con el objetivo de identificarlos y
evaluar su incidencia.
Materiales y métodos: Se realizó un estudio retrospectivo y descriptivo, analizando
historias clínicas de pacientes trasplantados renales con donante cadavérico en
el Servicio de Terapia Intensiva de nuestra Institución en el período
comprendido entre Marzo 2019 y Junio de 2022 con un total de 76 pacientes. Se
dividieron a los pacientes en dos grupos: aquellos que desarrollaron RFI y sin
RFI. Se analizaron las siguientes variables: edad y sexo del receptor,
antecedentes de hipertensión del donante, creatinina pre-ablación, tiempo de
isquemia fría y anastomosis, volumen urinario en las primeras 24 horas, SOFA y
Apache II, creatinina pre trasplante, entre otras.
Resultados: Se evaluaron
76 pacientes en el periodo preestablecido. La media de edad fue de 47,5 años y
el 53,9 % fueron hombres. Se observó una incidencia de RFI del 50,64%. En el
análisis univariado los factores de riesgo que mostraron diferencias
significativas para el desarrollo de RFI fueron Sexo, Apache II, Hipertensión
Arterial del donante (HTAd), Tiempo de Anastomosis (TA), Creatinina pre
trasplante, volumen urinario en las primeras 24 horas (Tabla 1). Al realizar el
análisis multivariado los factores que mantuvieron diferencias significativas
fueron: Sexo, Apache II, HTAd, Creatinina pre trasplante, volumen urinario en
las primeras 24h (Tabla 2).
Conclusiones: Se observó
que las variables que resultaron significativas para el desarrollo de retraso
en la función del injerto en relación al receptor fueron el Sexo masculino,
Apache II, Creatinina pre trasplante, volumen urinario en 24 horas. En relación
al donante la presencia de hipertensión Se necesita un trabajo con mayor número
de pacientes con análisis multivariado para establecer si el tiempo de
anastomosis resulta significativo para el desarrollo de RFI.


0307 CARACTERÍSTICAS Y
EVOLUCIÓN DE LA INFECCIÓN GRAVE POR SARS-CoV-2 EN PERSONAS VIVIENDO CON VIH
L De Vedia(1), V
Chediack(1), S Cáceres(1), D Dominguez(1), L Gonzalez(1), N De Grazia(1), O
Ortuño(1), V Auteri(1), P Velazquez(1), G Piovano(1), E Cortes(1), E Di
Virgilio(1), E Artigas(1), E Cunto(1)
(1) Muñiz.
Introducción: La infección por SARS-CoV-2 se asocia con
mayor mortalidad en pacientes que sufren diferentes comorbilidades. Sin
embargo, no está claramente establecido si, en los casos de COVID-19 grave o
crítico, las personas viviendo con VIH (PVV) constituyen un grupo con mayor
riesgo de mortalidad en comparación con los sujetos VIH negativos.
Objetivo: Comparar las características y evolución de
los pacientes con infección grave por SARS-CoV-2 en los grupos de PVV y sujetos
VIH negativos.
Materiales y método: Estudio observacional, descriptivo,
retrospectivo. Se incluyeron pacientes mayores de 18 años ingresados a la
unidad de cuidados intensivos (UCI) en un hospital terciario, entre marzo 2020
y julio 2022 por infección por SARS-CoV-2 y que sean portadores de VIH. Se
comparó con una cohorte de control de sujetos con COVID-19 grave/crítico
ingresado en una de las unidades de terapia intensiva del mismo hospital, pero
que eran VIH negativos. Se compararon las características demográficas y
clínicas, comorbilidades, y evolución (requerimiento de ventilación mecánica
(VM) y óbito). Se utilizó estadística descriptiva, y test- de Fisher para la
comparación, con un valor de significancia estadística de 0,05.
Resultados: Se incluyeron 52 pacientes con COVID-19 grave/crítico
VIH positivos y 341 sujetos con COVID-19 VIH negativos. No se observaron
diferencias significativas en cuanto a sexo y edad, ni en comorbilidades
asociadas. Entre los pacientes VIH positivos solo se realizó recuento de CD4+
en el 44% (23/52), con un valor promedio de 35,3 +/- 34,5 cel/mm3, y una
mediana de 22 cel/mm3. El grupo de PPV exhibió una tasa de requerimiento de VM
del 71,1% frente a un 63% del grupo control (p=0.25). La tasa mortalidad fue
superior en el grupo de pacientes VIH positivo (50% VS 37,5%), aunque no se
alcanzaron valores de significancia estadística (p= 0.08).
Conclusión: Si bien el número de pacientes incluidos es
pequeño, las PPV parecieran tener una tendencia hacia mayores posibilidades de
requerir VM o de fallecer cuando ingresan a UTI con un cuadro grave/crítico de
COVID-19 en comparación con los sujetos VIH negativos.
M Esperatti(1), NA
Fuentes(1), M Busico(2), M Olmos(3), A Gallardo(4), A Vitali(5), H Kakisu(3), J
Quintana(6), A Lagazio(5), S Saavedra(7), A Miranda(3), ME Gonzalez(1), M
Mogadouro(5), ACG High Flow And Prone Positioning
(1) Hospital Privado De Comunidad /
Universidad Nacional De Mar Del Plata. (2) Clínica Olivos Smg.. (3) Hospital
Privado De Comunidad. (4) Universidad De Morón. (5) Sanatorio De La Trinidad
Palermo. (6) Clínica Olivos Smg. (7) Hospital Aleman.
Introducción: La posición prona vigil (PPV) puede reducir
el riesgo de intubación endotraqueal (IET) en pacientes con insuficiencia
respiratoria asociada a Covid-19 que requieren alto flujo de oxígeno mediante
cánula nasal (CNAF). En el curso de la pandemia se modificaron múltiples
aspectos epidemiológicos y relacionados con la atención individual de los
pacientes pudiendo modificar el efecto de los tratamientos. Los efectos de la
PPV a nivel individual no han sido evaluados en las diferentes olas. Nosotros
evaluamos el efecto de la posición prona vigil sobre el riesgo de intubación
endotraqueal y de mortalidad en pacientes con Covid-19 tratados con CNAF, y
comparamos la magnitud del efecto entre la primera y la segunda ola en
Argentina.
Métodos: En este estudio multicéntrico de cohorte
prospectivo en 5 centros de Argentina, incluimos de forma consecutiva a
pacientes >18 años con COVID-19, insuficiencia respiratoria y requerimiento
de CNAF desde junio-2020 a septiembre 2021. La variable de exposición fue PPV
≥6 horas/día (mediante una intervención protocolizada), comparado con pacientes
que no realizaron PPV (NO-PPV-grupo control-). Se utilizó una ponderación de
probabilidad inversa (IPW-propensity score) para ajustar la probabilidad
condicional de tratamiento. Luego se realizó un ajuste por centro asistencial,
momento de la pandemia, y variables epidemiológicas (enfoque “doble robusto”).
El desenlace primario fue intubación endotraqueal y el secundario mortalidad
hospitalaria.
Resultados: Durante la primera y la segunda ola fueron
incluidos 360 y 368 pacientes-respectivamente-(Tabla 1); de ellos 195(54%) y
227(62%) fueron expuestos a PPV durante una mediana (p25 75) de 12 (10-16) y 14
(9-18) horas/día -respectivamente-. El análisis de propensión por IPW para cada
ola mostró diferencias estandarizadas <0,1 en todas las variables evaluadas,
cumpliendo con el supuesto de intercambiabilidad de las poblaciones. Los odds
ratio -OR- (IC95%) -ponderados y ajustados- para intubación endotraqueal en el
grupo expuesto a PPV durante la primera y la segunda ola fueron 0,25
(0.13-0.46) y 0.16 (0.09-0.31)-respectivamente- (figura 1). Los odds ratio
–ponderados y ajustados- para la mortalidad hospitalaria durante la primera y
la segunda ola fueron 0,35 (0.17-0.75) y 0.22 (0.12-0.46)-respectivamente-
(figura 1). No se observaron diferencias en la magnitud del efecto entre la
primera y la segunda ola para los desenlaces intubación endotraqueal (p=0.40)
ni para mortalidad hospitalaria (p=0.44) (Figura 1).
Conclusiones: En la población evaluada la posición prona
vigil redujo el riesgo de intubación endotraqueal y de mortalidad hospitalaria
sin observarse diferencias en esos desenlaces entre la primera y la segunda
ola.


L De Vedia(1), N
Lista(1), A Rodríguez(1), E Di Virgilio(1), M Peralta(1), M Flores Montes(1), G
Piovano(1), I Prieto(1), D Dominguez(1), V Auteri(1), E Artigas(1), L
Camargo(1), G Cabrera(1), M Cieslikowski(1), E Cunto(1)
(1) Muñiz.
Introducción: A pesar del uso generalizado del tratamiento
antiretroviral, las personas VIH positivos (VIH+) siguen teniendo un alto
riesgo de enfermedad crítica debido a la aparición de infecciones oportunistas
graves.
Objetivo: Describir las características de pacientes
VIH+ ingresados en Terapia Intensiva (TI) en los últimos 20 años, comparando su
evolución con la de los sujetos VIH negativos (VIH-).
Materiales y método: Estudio observacional, retrospectivo. Se
incluyeron pacientes VIH+ ≥18 años ingresados a TI en un hospital terciario,
entre 2002 y 2022, en comparación con pacientes VIH- ingresados en el mismo
período. Se evaluaron características demográficas y clínicas, y evolución
(requerimiento de ventilación mecánica [VM] y óbito). Se utilizó estadística
descriptiva, y test de Fisher o Student para las comparaciones, según
correspondiera, con un valor de p ≤ 0.05 para definir significancia
estadística.
Resultados: Se incluyeron 4963 pacientes (2088 VIH-, 2875
VIH+). En ambos grupos predominó el sexo masculino (VIH- 63,7%, VIH+ 63,3%).
Los pacientes VIH+ tuvieron un promedio de edad significativamente inferior
(39,7 ± 9,9 vs 48,8 ±17,2, p<0,001). Se contaba con recuento de CD4+ en el
45,5% de los casos VIH+, con una mediana de 45 cel/mm3. El 84,1% tenía CD4+
<200 cel/mm3, y el 15,8% CD4+ ≥200 cel/mm3. Los pacientes VIH+ tuvieron
mayores tasas de requerimiento de VM (32% vs 24%, p<0,001) y mortalidad
(29,8% vs 17m2%, p<0,001). Los pacientes VIH+ con CD4+ <200 cel/mm3
tuvieron una tasa de VM del 34,5% y una mortalidad del 32,2% (en ambos casos p=
<0.0001 vs VIH-), mientras que aquellos con CD4+ ≥200 cel/mm3, la tasa de VM
fue del 22,7% (p=0,68) y la de mortalidad fue del 14,6% (p=0,35 vs VIH-). El
análisis de regresión logística mostró que tener CD4+ <200 cel/mm3 se asoció
con un mayor riesgo de mortalidad (OR 2,92, IC 95% 1,91-4,48), mientras que
tener un recuento de CD4+ ≥200 se asoció con un riesgo reducido (OR 0,34, IC
95% 0,22-0,53).
Conclusión: Los pacientes VIH+ que ingresan a UTI y que
tienen un recuento de CD4+ + <200 cel/mm3 constituyen una población con
mayor riesgo de requerimiento de VM y mortalidad.
0314 EXACERBACION DE SINDROME DE
YAO EN UNA PACIENTE NEUROCRITICA. REPORTE DE UN CASO
RA Ojeda(1), YM
Lamberto(1), AC Dinuzzo(1), A Violo(1), DV Toledo(1), R Lobo Herrera(1), JA
Sereno(1), ME Centurion(1), MA Montenegro(1), LJ Degregorio(1), MC Carruega(1),
PJ Marconi(1), MF Alsina(1), EP Mikulic(1)
(1) Hospital Militar Central.
Introducción: El síndrome de Yao, también conocido como
enfermedad autoinflamatoria asociada a NOD2 (nucleotide binding oligomerization
doman containing 2), es un proceso genético caracterizado por episodios de
fiebre e inflamación anormal que afecta diversas partes del organismo,
particularmente la piel, las articulaciones y el sistema gastrointestinal. El
gen NOD 2 codifica la proteína NOD2 cuya función es activar algunos tipos de
células del sistema inmunitario entre otras.
Presentación del caso: Mujer de 20 años que ingresa a Terapia
Intensiva en postoperatorio de exéresis de tumor occipital basal derecho. A su
ingreso, presenta falla renal y plaquetaria, posteriormente evoluciona con
deterioro del sensorio y convulsiones, tomografía de cerebro hematoma pequeño
en sitio quirúrgico. Evoluciona con mala mecánica ventilatoria requiriendo
ventilación mecánica y progresión de falla hematológica, renal, hepática y
hemodinámica. Se evaluaron como diagnósticos diferenciales exacerbación de
patológica de base y shock séptico, por lo cual se decidió tratamiento
antibiótico de amplio espectro y Servicio de Inmunología indico
Inmunoglobulinas y posteriormente corticoides a altas dosis. Requirió soporte
transfusional por plaquetopenia y coagulopatía. Evoluciona posteriormente con
mejoría de las fallas, lográndose su extubación al doceavo dia de internación.
Fue externada al día veinticinco, sin secuelas clínicas.
Discusión: El síndrome de YAO es una patología poco
conocida, mucho menos para el ámbito de la medicina intensiva, en el caso de la
paciente presentada, la sospecha de exacerbación frente al stress de una
neurocirugía resulto en un cuadro de riesgo de vida con falla multiple de
órganos y que requirió el manejo interdisciplinario para lograr la mejoría.
Conclusiones: El síndrome de YAO constituye un cuadro grave
infrecuentemente descripto. En la escasa literatura se destaca la falta de
consenso en cuanto al abordaje del mismo. Es fundamental mantener un nivel de
sospecha para detectar esta patología y tener en cuenta las posibles
complicaciones frente al paciente con este diagnostico.

M Montenegro(1), MC
Vignetta(1), P Pahnke(1), E Dantur(1), G Solla(1), AO Ohanian(1), M Crespo(1),
A Fabre(2), A Storniolo Squintone(2), D Dib(2), A Lopez(1), I Herrero(1), I
Ocampo(1), V Vignolo(1)
(1) Hospital Municipal Urgencias. (2) Instituto
De Medicina Forense.
Introducción: La inyección de componentes sintéticos con
fines estéticos, datan desde hace más de un siglo. Grupos poblacionales buscan
alternativas caseras y económicas, realizadas por legos, con consecuencias que
van desde reacciones locales, SIRS,ASIA, embolias sistémicas y muerte.
Presentación: Femenino, 28 años. Ingreso: dolor generalizado,
astenia, hiporexia, induración en abdomen y miembros inferiores secundarios a
inyección de sustancia desconocida en mamas. Examen Físico: bradipsiquia, mamas
eritematosas con nódulos dolorosos. Miembro inferior eritema en parches. Sin
signos tomográficos de TEPA. Diagnóstico: Reacción inflamatoria sistémica
secundaria a biopolímero inyectable - Shock séptico. Tratamiento: vasopresores,
antibióticos, analgesia, antihistamínicos y corticoides. Mala evolución. IRM
reprogramada. 14 días post-inyección (DPI), TAC tórax con infiltrados
alveolointersticiales en parches compatibles con embolia pulmonar. 21 DPI:
toilette quirúrgico de mamas, previo procedimiento ceguera derecha. Sin
respuesta ante retirada de sedoanalgesia. TAC cerebral: sin lesiones. Drenaje
de colección oleosa en tobillo. Cultivos: Achromobacter xylosoxidans,
tratamiento dirigido. 25 DPI midriasis bilateral. TAC: hidrocefalia con
hipodensidad de la sustancia blanca circundante y ECD. Muerte encefálica.
Donación rechazada. Anatomía patológica: congestión y edema en cerebro y pulmón
compatibles con micro trombosis. Tejidos blandos cervicales y mediastinales,
pericardio parietal, glándula mamaria y tejido celular subcutáneo abdominal con
reacción de tipo cuerpo extraño y abscedación relacionados a espacios
pseudoquisticos vacíos. (Compatibles con material oleoso). Congestión visceral.
No pudo identificarse el material inyectado.
Discusión: La alogenosis iatrogénica afecta a más de un
millón de personas/año mundialmente. Las embolias sistémicas ocurren 1 a 2% con
alta mortalidad, producidas por inyección intravascular accidental y directa o
lesión vascular-capilar pudiendo afectar a cualquier órgano de la economía. La
afectación neurológica generalmente resulta fatal con lesión e hipoxia tisular.
Entre más temprano se presenten los síntomas, mayor severidad y mal pronóstico
con una alta tasa de mortalidad. El tratamiento es sintomático y de sostén,
siendo un reto para la medicina moderna.
Conclusión: La inyección
ilícita de materiales ilegales en el cuerpo con fines estéticos sigue siendo
una práctica habitual cuyo único tratamiento disponible es la prevención. Hasta
donde sabemos, no hay casos en la bibliografía que mencionen muerte encefálica
secundaria a hidrocefalia por embolia de material sintético inyectado.


0317 SINDROME
POSTPERICARDIOTOMIA TRAS CIRUGIA CARDIACA
J Quiroz Cedeño(1),
G Monti(1), F Perez(1), G Gaudenzi(1), P Verta(1), M Rolando(1), O
Ferrufino(1), K Banzer(1), M Mansur(1), K Gamarra(1), A Canchila(1), D
Parraga(1), A Fernandez(1), A Gonzalez(1), D Mingoni(1)
(1) Central San Isidro.
Introducción: Se reporta una incidencia de un 21 a 29% de
este síndrome, por lo cual a propósito de un caso se plantea una revisión sobre
esta patología, asociada a un abordaje terapéutico precoz e invasivo a fin de
mejorar la morbimortalidad asociada a la enfermedad severa.
Caso clínico: Masculino de 60 años con múltiples
antecedentes, el más relevante un reemplazo de válvula aortica y plástica de
válvula mitral (septiembre 2021). Consulta en noviembre 2021 con disnea clase
funcional II-III. Se interpreta como insuficiencia cardiaca descompensada por
infección urinaria con urocultivo patológico. Horas después presenta
desorientación temporoespacial, mala mecánica ventilatoria, e hipoperfusión
tisular, se realiza intubación orotraqueal y tomografía donde visualiza
cardiomegalia con derrame pericárdico severo. Ecocardiograma informa derrame
pericárdico severo, se realiza pericardiocentesis (3 oportunidades).
Ecocardiograma transesofagico informa Fey del 40%, prótesis valvular aortica
normofuncionante, plástica mitral conservada y derrame pericárdico leve.
Cirugía de tórax realiza ventana pericárdica con colocación de tubo de
avenamiento pleural. Traqueotomía por weaning dificultoso, se decánula,
posterior evolución favorable y egreso hospitalario.
Discusión: Patología caracterizada por dolor precordial
típico, frote pericardico a la auscultación, laboratorio perfil inflamatorio
elevado, ecocardiograma derrame pericárdico masivo que por colapso de cavidades
derechas causa taponamiento cardiaco. Electrocardiograma bajo voltaje, onda T
invertida, segmento ST oscilante. Diagnósticos diferenciales: dolor incisional,
neumonía, mediastinitis, endocarditis, insuficiencia cardiaca congestiva,
infarto agudo de miorcardio, tromboembolismo pulmonar, disección aortica. Se
sugiere considerarlo junto con estas causas.
Conclusión: Un abordaje precoz de esta patología como
posible diagnóstico de ingreso, puedo disminuir la estancia hospitalaria y así
disminuir el porcentaje de mortalidad. Se concluye que aunque no es frecuente
que este síndrome, luego de la cirugía de corazón o de lesión, influya en el
pericardio, es importante tenerlo en cuenta, ya que puede implicar una
confusión diagnóstica en la práctica cotidiana y es necesario conocer sobre su
existencia, características y tratamiento adecuado.


0318 CUANDO LA INTERPRETACION
DEL ESTADO ACIDO-BASE ES LA CLAVE DEL DIAGNOSTICO. REPORTE DE UN CASO
CM Dimarco(1), G
Velazco(2), V Saucedo(2), C Lopez(2), S Saltarelli(2), G Fernandez(2), S
Alvarez(2), S Saracco(2)
(1) Hospital Central De Mendoza. (2) Hospital
Central.
Introducción: El etilenglicol, incoloro e inodoro y de pH
neutro es usado como disolvente, fluidos para frenos y refrigerante; cuando es
ingerido accidental o intencionalmente, causa intoxicaciones con elevada
morbimortalidad y daños irreversibles si no se trata con celeridad. Se absorbe
por tracto gastrointestinal (pico plasmático 1-4hs). Bajo volumen de
distribución, vida media 3hs (18hs con etilterapia). Se metaboliza en hígado
(80%), por la enzima alcohol deshidrogenasa (NADP+) a glicoaldehído y ácidos
glioxílico, fórmico y oxálico, responsables de su toxicidad. Esta se
caracteriza por acidosis metabólica severa con GAP aumentado, hipocalcemia y
oxalatos de calcio en orina. Debe ser diagnosticada y tratada rápidamente, ante
sospecha clínica, fundada en la exposición e interpretación de laboratorio. Es
prioritario el uso de antídotos, como etanol o fomepizol, inhibidores de la
NADP+, que prolongan la eliminación del etilenglicol y reduce la formación de
metabolitos tóxicos.
Caso clínico: Mujer de 65 años. Antecedentes de: obesidad,
hipertensión, depresión, tabaquismo. Ingresó por trastorno de conciencia
cuali-cuantitativo. Glasgow: 6/15. Inestabilidad hemodinámica. Paro cardio
respiratorio 5 minutos. Tomografía de cerebro sin lesiones, leucocitosis
formula conservada; punción lumbar con hiperglucorraquia, hiperproteinorraquia,
lactato de 6,8 mol/l. Inició tratamiento cubriendo foco meníngeo. Además,
presentaba acidosis metabólica con GAP aumentado (27.4), hiperlactacidemia
(29mmol/l), hipocalcemia (69.7mg/l), cristales de oxalato de calcio en orina;
Se analizan causas de hiperlactacidemia por ganancia de ácidos externos y
exhaustivo reinterrogatorio a familiar que posteriormente encuentra el envase
del refrigerante. Se reinterpreta el cuadro clínico y se inicia etilterapia al
20% por SNG (aproximadamente 20hs pos ingesta) y hemodiálisis por anuria.
Evolución favorable, extubada al 13° día con cambio de interfaz.
Conclusión: La intoxicación por glicoles es poco
frecuente y potencialmente letal, debe sospecharse, ante la presencia de
compromiso neurológico de etiología no determinada y acidosis metabólica severa
con GAP aumentado, acompañada de hipocalcemia, cristaluria de oxalatos de
calcio e insuficiencia renal aguda o fallo multiorgánico de origen desconocido.
El tratamiento es la etilterapia, hemodiálisis y medidas de soporte vital. El
etanol se administra por vía oral o EV, con dosis de carga y mantenimiento hasta
que los trastornos hidroelectrolíticos se resuelvan.

0319 DIABETES ÍNSIPIDA CENTRAL
EN HISTIOCITOSIS DE LANGERHANS
J Quiroz Cedeño(1),
G Monti(1), M Mansur(1), G Gaudenzi(1), M Rolando(1), K Banzer(1), O
Ferrufino(1), F Perez(1), D Parraga(1), K Gamarra(1), A Canchila(1), A
Fernandez(1), A Gonzalez(1), D Mingoni(1)
(1) Central San Isidro.
Introducción: Existe asociación directa entre el
diagnostico de Histiocitosis de Langerhans y el desarrollo de Diabetes Insípida
Central en un 50% de los casos, ya sea, por infiltración directa del eje
hipotálamo-hipofisario o como síndrome paraneoplásico.
El diagnostico de Diabetes Insípida Central
obliga a descartar el diagnostico de Histiocitosis de Langerhans.
Presentación del caso: Paciente masculino de 39 años ingresa para
excéresis de lesión osteolítica fronto-parietal izquierda descripta en RMN de
encéfalo como formación solido-quística ubicada en convexidad frontoparietal
izquierda, en situación extraaxial, con extensión extracraneal.
Paciente refiere cuadro clínico de 1 año de
evolución caracterizado por cefalea hemicraneana izquierda asociado a lesión
fluctuante en región frontoparietal ipsilateral, poliuria y polidipsia.
En postoperatorio, se constatan registros de
diuresis compatibles con poliuria. Se solicita análisis de orina al azar que
evidencia densidad y osmolaridad urinaria disminuidas, sin alteraciones a nivel
hidroelectrolítico. Se decide realizar prueba de deprivación de líquidos,
confirmando el diagnóstico de diabetes insípida central.
Se inicia tratamiento con desmopresina con
resolución sintomática.
Posterior al alta hospitalaria, se recibe
informe de anatomía patológica de lesión ósea con diagnóstico de Histiocitosis
de Langerhans. Paciente en seguimiento para tratamiento de enfermedad primaria.
Discusión: La Histiocitosis de Células de Langerhans
consiste en la expansión monoclonal de células dendríticas mieloides. Su órgano
blanco es el tejido óseo.
El diagnostico, más frecuente, en la
infancia, puede darse en edad adulta.
La Histiocitosis de Langerhans se asocia en
un 50% de los casos con el desarrollo de Diabetes Insípida Central, precediendo
en ocasiones, a la aparición de lesiones óseas.
Conclusión: El diagnostico de Diabetes Insípida Central
obliga a descartar la Histiocitosis de Langerhans como probable etiología, ya
que, en ocasiones, precede a la aparición de lesiones óseas.
La evolución de ambas entidades es paralela e
instalado el diagnostico de Diabetes Insípida Central, el control de su
etiología no genera su resolución.
La sospecha clínica es fundamental para
arribar al diagnóstico precoz y evitar complicaciones.

0320 Reporte de Caso:
Meningoencefalitis asociada a Covid-19
G Fernández(1), S
Barrionuevo(1), V Cuéllar(1), H García(1), ME Giménez(1), R López(1), MM
Tártara(1), S Urbano(1), S Viera(1), R Vargas Martínez(1), L Migliacci(1)
(1) Cl Pueyrredón.
En contexto de pandemia por Covid-19,
diferentes manifestaciones clínicas significaron un reto para los profesionales
sanitarios. Los pacientes con signo-sintomatología neurológica, produjeron
retraso diagnóstico y terapéutico.
Caso clínico: Masculino, 61 años, Antecedente Reemplazo
Válvula aórtica-protésica, anticoagulado con dicumarínicos. Hipertenso,
dislipémico, Compresión medular secundario a epéndimoma cervicodorsal.
Ingresa 12/2020 con paresias 2/5(escala MRC)
miembro inferior izquierdo. Hiporreflexia, mioclonías, que progresa a
paraplejía, arreflexia de miembros inferiores, Babinski, sensibilidad
disminuida desde territorio T10. Se decide rotar a Enoxaparina previo a
resolución quirúgica cirugía radicular.Evoluciona con stroke isquémico
frontoparietal derecho con posterior transformación hemorrágica. Evidencia de
infiltrados pulmonares bilaterales en vidrio esmerilado. Necesidad de
Intubación orotraqueal, Ventilación Mecánica y evacuación de hematoma
intracerebral. Posterior Hipertensión Endocraneana normalizada con tratamiento
osmótico. Por encefalopatía, fiebre y status epiléptico no convulsivo, Segunda
muestra Aspirado traqueal positica para Covid, se realiza Punción Lumbar PCR
COVID (+). Tratamiento de sostén. Presenta recuperación consciencia con
hemiplejía facio-braqui crural izquierda. Es dado de alta de Terapia Intensiva
a los 52 días de internación. Evoluciona con nueva infección asociada a los
cuidados de la salud con Disfusión Orgánica Múltiple. Fallece día + 95
internación.
Discusión:La Meningoencefalitis por COVID-19, entidad
descrita recientemente, cuya fisiopatología se desconoce, sin disponer de
tratamiento. El compromiso neurológico es una presentación atípica (5-8%) por
su capacidad neuroinvasora, neurotrópica ocasionando polineuropatías,
convulsiones, psicosis y/o accidentes cerebrovasculares.
Conclusión: El diagnóstico se debe considerar durante la
pandemia, antecedentes de exposición, alteraciones neurológicas, LCR normal o
patológico, citoquímico con leucocitos ligeramente aumentada o normal,
normoglucorraquia, proteínas normales o hiperproteinorraquia leve, como en
otros cuadros virales, inflamatorios.


0321 El uso de sedoanalgesia en
Pandemia por SARS-COV-2 y su impacto en un hospital Monovalente
MJ Ochoa(1), D
Raggio(2), MJ Ochoa(2), E Cunto(2), M Quinteros(2), S Krugliansky(2)
(1) F. J. Muñiz. (2) F. J. Muñiz.
Introducción: El Hospital de Infecciosas Francisco Javier
Muñiz fue designado por el Ministerio de salud de la Ciudad de Buenos Aires
como Centro De Referencia para pacientes con SARS-COV-2
Desde el 3 de marzo del 2020, con la
aparición del primer caso en Argentina,el hospital inició un proceso de
reestructuración y capacitación del personal para dar respuesta a las
necesidades sanitarias de ese momento.
La Farmacia tuvo que adaptarse al aumento de
la demanda de medicación para sedoanalgesia para llevar a cabo los tratamientos
contra esta enfermedad. El conocer el comportamiento durante la pandemia en el
hemisferio Norte nos permitió prever el stock para la provisión de la
medicación en tiempo y forma.
Incluyen en esta etapa el uso de analgosedación
para pacientes de unidades críticas.
Objetivos: Determinar el aumento de consumo de fármacos
de sedoanalgesia para evaluar el impacto que tuvo en el servicio de farmacia y
en las terapias intensivas del Hospital Muñiz.
Métodos: Estudio observacional retrospectivo sobre el
consumo de determinados fármacos para uso de analgosedación en la terapia
intensiva del Hospital Muñiz durante el período Abril 2019- 2020 Octubre 2019
-2020. Estos datos se obtuvieron en base al registro de consumo de las salas de
internación del sistema informático SIGEHOS2.
Conclusiones: Tras el análisis podemos afirmar que el
hospital durante la pandemia de SARS-COV-2 en los períodos analizados
incrementó tres veces la capacidad de la terapia intensiva, el uso y la
dispensa de medicación para sedoanalgesia se triplicó, a pesar de ello, gracias
al trabajo en equipo e interdisciplinario, pudo adaptarse a los cambios
producidos por esta nueva infección sin dejar de atender las patologías propias
de un hospital monovalente especializado en enfermedades infecciosas y supo
responder positivamente al requerimiento, asegurando la disponibilidad de
medicamentos y manteniendo la atención farmacéutica.
Bibliografía: Guía para farmacéuticos ante faltantes de
sedantes, analgésicos y relajantes musculares durante la pandemia de
SARS-COV-2.
Versión 00- vigencia 30/05/2021.
Asociación Argentina de Farmacéuticos de
Hospital.


PL Bureu(1), PL
Bureu(2), SM Romero Baldoni(2), MI Subira(2)
(1) Hospital Regional “victor Sanguinetti”.
(2) Regional.
Introducción: El manejo no quirúrgico del trauma abdominal
cerrado se emplea desde hace más de 40 años con éxito en lesiones hepáticas y
esplénicas independientemente del grado de lesión en aquellos pacientes que
estén hemodinámicamente estables.
Caso: Paciente de 4 años, ingresa a guardia luego
de sufrir politraumatismo al ser aplastada por un chulengo, con compromiso de
cráneo, tórax y abdomen. Ingresa a UTIP hemodinamicamente compensada, con
ventilación espontánea, abdomen blando, depresible. A las dos horas presenta
desmejoría, se sospecha lesión hepatoesplénica y se interconsulta al cirujano
de pasiva, esperando disponibilidad de quirófano se logra estabilidad
hemodinámica, por lo que se decide conducta conservadora.
A las 72 hs se realiza nueva tomografía donde
se observa derrame pleural bilateral, contusión pulmonar bilateral, ascitis,
Hígado con laceración entre los segmentos IV y II-III, hematoma parenquimatoso
profundo en segmento II-III, Bazo con hematoma subcapsular con compromiso mayor
al 50 % de su superficie. Se realiza paracentesis evacuatoria 1830 ml y se colocan
tubos de avenamiento pleural obteniendo liquido sanguinolento.
Evoluciona presentando diversas
complicaciones, a los 24 días de internación por distensión abdominal se
realiza paracentesis obteniéndose liquido biliar por lo que se realiza cirugía
exploradora donde no se observan lesiones de conductos biliares.
El día 27 de internación pasa a sala.
Discusión: Durante los últimos años, el manejo del
traumatismo abdominal cerrado ha evolucionado desde un tratamiento quirúrgico
con alta tasa de morbimortalidad a un tratamiento no quirúrgico exitoso incluso
en lesiones hepática y esplénica de alto grado. El pilar del manejo no
quirúrgico es la estabilidad hemodinámica, independientemente del grado de
lesión tomográfica. La definición de estabilidad hemodinámica en los pacientes
con trauma abdominal, no está bien establecida.5, 6 y muchas veces es difícil
de determinar.
En nuestro caso clínico, la decisión de
continuar con tratamiento no quirúrgico fue muy discutida.
Conclusión: El tratamiento conservador es de elección
para el trauma abdominal cerrado con lesión hepática y esplénica, teniendo una
alta tasa de éxito y baja mortalidad. Se necesitan nuevos estudios para la
detección temprana de indicadores de fracaso en el tratamiento no quirúrgico.
0324 COAGULOPATÍA INDUCIDA POR
COVID. REPORTE DE CASO
JJ Cáceres(1), FD
Vasile(1), MA Vega(1), DA Sittoni(1), JR Bagnasco(1), NV Luna(1)
(1) Domingo Funes.
Introducción: La incidencia de ACV-isquémico agudo en
COVID-19 oscila entre 2,5% y 5%.
Se ha establecido una relación entre
incidencia de ACV y severidad de la infección SARS-CoV2, casos leves es menor
al 1% y severos aumenta hasta 6%.
De acuerdo con datos del RACCOVID, de 2728
pacientes, 15,3% (420) presentó alguna complicación cardiovascular y de éstos,
131 presentaron daño miocárdico (31,3%), la mayoría (77-58,7%) manifestada por
injuria miocárdica. 24 presentaron IAMCEST y 29 IAMSEST.
Presentación: Masculino de 48 años, antecedentes DBT,
tabaquista y sin vacunas para SARS-CoV2. Consulta por disnea, tos, decaimiento,
febrículas y dolor epigástrico de 48hs evolución.
EF: crepitantes bibasales, glasgow 14/15,
parafasia y ecolalia.
CSV: FR= 24-FC= 98-SatO2= 93%-Temp= 37,8°C-TA=
145/90mmHg.
ECG: signos de isquemia evolucionada en cara inferior
e isquemia subepicárdica en cara anterior. TAC cerebro hipodensidad en región
parieto-temporal izquierda, tórax infiltrados intersticiales bilaterales tipo
vidrio esmerilado. PCR-covid negativa.
Laboratorio: Troponina-I 13644; PCR 94.2;
Dímero-D 868; Nt-proBNP 1318; Plaquetas 270000; APP 110%; KPTT 27. Control
Troponinas-I 12077.
Inicia oxigenoterapia con CNAF, doble
antiagregación , anticoagulación con HBPM.
Ecocardiograma doppler objetiva hipocinesia
parietal inferomedial, inferior basal y lateral posteromedial.
Diagnóstico: IAM-NOSTEMI cara inferior
evolucionado, NAC-bilateral y ACV-isquémico.
48hs del ingreso evoluciona tórpidamente,
requiriendo VMI. Repite PCR-covid, resultado positivo. Comienza tratamiento con
remdesivir y metilprednisona. 13 días de AVM, se realiza destete, continua
internación en clínica médica esperando cinecoronariografía.
Discusión: La coagulopatía inducida por COVID-19, puede
presentarse con enfermedad tromboembólica venosa o arterial, habitualmente
correlacionada con evoluciones tórpidas y elevada morbi-mortalidad.
Los mecanismos fisiopatológicos involucrados
son:
Incremento de actividad simpática asociada a
infecciones en pacientes con enfermedad coronaria previa.
Sepsis como precipitante de IAM tipo-II
El COVID-19 estimula un proceso
trombo-inflamatorio, tormenta de citoquinas que puede acelerar la formación de
nuevas placas ateroscleróticas coronarias, su desestabilización y ruptura.
Las diferencias con coagulopatías habituales
de pacientes críticos, CID (Coagulación Intravascular Diseminada) y MAT
(Microangiopatía Trombótica) es que la CIC-19 presenta Dímero-D elevado,
plaquetas normales y coagulograma normal.
Conclusión: Es importante tener en cuenta en todos los
pacientes con Covid-19 el riesgo de ETV-ETA, ya que la instauración rápida del
tratamiento anticoagulante mejora supervivencia y reduce secuelas. Este caso,
el diagnóstico oportuno de ambas complicaciones cardiovasculares simultáneas
que presentó el paciente, permitió iniciar el tratamiento anticoagulante y
mejorar pronóstico.


0325 REPORTE DE CASO: FALLO
RESPIRATORIO POR QUISTE DE VALÉCULA Y MANEJO EN LA URGENCIA
M Enriquez
Gentile(1), L Martinez(1), C Mena(1), A Bottaro(1), D Natta(1), P Medici(1), M Nogueira(1),
J Gonzalez(1), D Jauregui(1)
(1) Hospital Materno Infantil Mar Del Plata.
Introducción: El quiste de valécula es una entidad
infrecuente en pediatría, incluido en las malformaciones congénitas de laringe.
Su incidencia exacta es desconocida. Se estima que representa 10,5% del total
de quistes laríngeos congénitos, cuya incidencia anual es 1 por 300.000
nacimientos.
Las manifestaciones clínicas son variadas,
dependiendo del tamaño y localización del quiste.
La importancia de su conocimiento, radica en
la potencial morbimortalidad, por lo que se reporta este caso.
Presentación de caso: Varón, 2 meses, antecedente de pretérmino (34
semanas) y distrés respiratorio al nacer que requirió asistencia respiratoria
mecánica.
Presenta episodios de apnea e intolerancia
oral. Se sospecha sepsis, y se obtiene en aspirado nasofaríngeo parainfluenza.
Se realizan repetidos intentos fallidos de ventilación evidenciándose en
laringoscopía imagen quística redondeada en valécula, que desplaza epiglotis,
obstruyendo la luz. (fig1) Otorrinolaringología, realiza laringoscopía directa.
Drena quiste por punción con fibroendoscopio, y coloca tubo orotraqueal. Se
programa resección quirúrgica por marsupialización, diferida. Postcirugía se
extuba con buena evolución clínica.
Discusión: Los quistes de valécula son infrecuentes,
causan signosintomatología que puede confundirse con patología frecuente del
lactante, como estridor, distrés, disnea, disfonía, cianosis, tos, retraso
pondoestatural, disfagia hasta muerte súbita. Pueden exacerbarse con
infecciones respiratorias del tracto superior.
La laringoscopía directa es el método
diagnóstico de elección porque permite realizar diagnósticos diferenciales.
Otros estudios complementarios son resonancia
magnética nuclear y tomografía computada, pero requieren sedación e
instrumentalización de via aérea. La ecografía y radiografía cervical presentan
escaso valor diagnóstico.
El tratamiento es quirúrgico. Debe realizarse
bajo visualización directa con fibrobroncoscopía o laringoscopía. La punción
aspirativa es útil en la urgencia cuando se debe instrumentalizar vía aérea. El
tratamiento definitivo es la marsupialización o exéresis completa del quiste,
con baja tasa de recurrencia, sin diferencia significativa entre los métodos.
Conclusión: El quiste de valécula es infrecuente. Debe
considerarse como posible diagnóstico ante signosintomatología compatible con
obstrucción de la vía aérea. Su intervención temprana previene un descenlace
fatal.

0326 MIOCARDITIS POR SAR COV-2
EN PACIENTE INMUNOCOMPROMETIDA. Reporte de caso
G Fernandez(1), V
Cuéllar(1), C Miglioranza(1), S Viera(1), P Dominguez(1), N Rizzo(1), P
Zenón(1), P Artaza(1), A Bucci(1), H García(1), R López(1), MM Tártara(1), S
Urbano(1), L Migliacci(1), P Verón(1)
(1) Cl Pueyrredón.
Presentación: Mujer, 20 años, antecedente de: Lupus;
Fibromialgia; HIV(+); vacunación incompleta para SARS COV-2.
Ingresa a UTI por intenso dolor
centrotorácico y disnea CF :III-IV . Presenta: bicitopenia.Troponina:186 . Se
descarta TEP por angiotc. Sospecha de infección respiratoria SARS-COV 2 vs
neumonía asociada a los cuidados de la salud. (internación 15 días previos
tratamiento del dolor)
Se realizan : policultivos, HNF para
Covid-19, inicia antibióticos empírico. Requiere: CAFO2.
HNF COVID-19: (+). Inicia: corticoides y
Cánula Alto Flujo: Evoluciona con fiebre, excitación psicomotriz,
taquiarritmia: fibrilación auricular alta pasaje con posterior parada
cardio-respiratoria: maniobras de RCP avanzada. Recupera ritmo cardíaco
.Evoluciona con disfunción orgánica múltiple y SDRA. Laboratorio:Descarta
reactivación lúpica.
Datos+: TGO:2536. TGP:1807 ProBNP:12.221
Troponinas:2500 PCR:192
Ferritina 1650 DD 4500 LDH = 4000 Ac.láctico
:135. ante sospecha de miocarditis se realiza ecocardiograma: hipoquinesia
severa difusa, FEY : 25%. Tratamiento de sostén.
Lenta estabilización de los parámetros
hemodinámicos y respiratorios. Con Ecocardiograma a los 15 días con notable
mejoría: FEY: 48%, sin embargo desarrolla encefalopatía post anóxica, en
tratamiento rehabilitación.
Discusión: La enfermedad por COVID-19 se asocia con
múltiples complicaciones cardiovasculares. Estudios documentaron entre 7-17% de
los pacientes hospitalizados presentaron injuria miocárdica aguda.
Conclusión: Existen varias hipótesis del mecanismos de
injuria miocárdica asociadas a COVID-19, el diagnóstico se basa en la alta
presunción diagnóstica y signos de miocarditis en los estudios complementarios.
El compromiso cardiovascular se lo debe tener presente ,por la alta
morbimortalidad asociada y la rápida evolución del cuadro.


SP Chapela(1), F
Gutierrez(2), EJ Descotte(2), MJ Reberendo(2), ND Llobera(2), M Pozo(2), SP Chapela(2)
(1) Hospital Britanico. (2) Hospital
Británico De Buenos Aires.
Introducción: La determinación del gasto calórico en los
pacientes críticamente enfermos es fundamental para realizar el aporte
nutricional adecuado. El método gold standard para la medición del gasto
calórico es la calorimetría indirecta. En la práctica diaria es infrecuente su
utilización y suelen usarse métodos alternativos para la estimación como el
método de Fick.
Objetivos: Comparar el gasto calórico de pacientes
crìticamente enfermos medido con calorimetría indirecta o con el método de Fick
calculado con dos formas de medición del gasto cardiáco (no invasiva y
mínimamente invasiva).
Métodos: Se incluyeron pacientes críticos en
ventilación mecánica a los que se les realizó calorimetría indirecta, de
acuerdo a indicación de los equipos tratantes. Simultáneamente se realizó un
extracción sanguínea arterial y venosa y una medición del gasto cardiaco con
ecografía transtorácica o con un método de monitoreo del gasto cardíaco
mínimamente invasivo (EV1000 clinical platform, Edwards Lifescience, Irvine,
Ca. USA) con lo que se realizó el cálculo del gasto calórico con el método de
Fick.
Se realizó un análisis de correlación con el
método de Pearson o Spearman y el método gráfico de Bland Altman para evaluar
la concordancia.
Resultados: Se evaluaron 28 pacientes cuyas
características basales se muestran en la tabla 1. No hubo correlación entre el
gasto calórico medido por calorimetría indirecta y medido por monitoreo
hemodinámico mínimamente invasivo en 15 pacientes críticamente enfermos y con
ventilación mecánica (rho=-0.11, p=0.70). Tampoco hubo correlación entre el
gasto calórico medido por calorimetría indirecta y medido por ecocardiografía
en 16 pacientes(rho=-0.20, p=0.46).
Se realizó una evaluación gráfica con el
método de Bland y Altman para ambas comparaciones observándose en ambos casos
una baja concordancia con un error sistemático amplio y una dispersión de datos
que supera los valores absolutos de gasto calórico medidos en los pacientes
(gráfico 1).
Conclusión: En nuestra población de pacientes
críticamente enfermos no existe adecuada concordancia entre el método Gold
Standard de medición del gasto calórico con su cálculo utilizando el método de
Fick con medición del gasto cardiaco con dispositivos no invasivos o
mínimamente invasivos.


0328 Utilidad de la vena
yugular interna para hemodiálisis de urgencia en pacientes ortopneicos
R Karatanasopuloz(1),
MM Barraza(2), Vidal, SA Gimenez
Pedemonte(4), JC Florez(4), A Serruya(4), G Levy(4), L Gossen(4), MF
Mendieta(4), C Joachin(4)
(1) Vidal. (2) J.r. (3) Vidal. (4) J R Vidal.
Introducción: En pacientes que requieren terapia de reemplazo
renal la sobrecarga de volumen representa un cuadro grave; y en pacientes que
no responden al tratamiento médico, se requiere hemodiálisis de urgencia con
colocación de catéter doble lumen. Para ello la posición del paciente es
crucial, optándose habitualmente por el decúbito dorsal. En muchos casos la
misma no se puede adoptar por ortopnea por lo cual utilizamos la vena yugular
interna por vía media con el paciente semisentado guiados por ecografía
Objetivos: Describir la utilidad del acceso a la vena
yugular interna en posición semisentada obligada con guía ecográfica en
aquellos pacientes que presentan ortopnea y requieren catéter doble lumen para
la realización de hemodiálisis de urgencia
Materiales y Métodos: Se describe la técnica y complicaciones de
los pacientes a los cuales se les colocó catéter doble lumen en la vena yugular
interna por vía media en posición semisentada con guía ecográfica, con aguja
perpendicular a la cama y el paciente a 45 grados, durante el periodo 1/1/2007 y
el 1/1/22, Se incluyeron pacientes con insuficiencia renal aguda y edema
pulmonar.
Discusión: Se analizó en total la realización de 100
accesos con esta técnica, la yugular derecha fue utilizada en 61 pacientes. Las
complicaciones observadas fueron sangrado autolimitado del sitio de punción en
10 casos
Conclusión: El acceso a la vena yugular en posición
semisentada con guía ecográfica es una alternativa útil para la colocación de
catéteres para hemodiálisis en pacientes con urgencia dialítica y ortopnea
M Galindo(1), P
Saul(1), MDLM Nano(1), G Sandez(1), F Gil Zbiden(1), JM Fernandez(1), C Vargas(1),
N Campagnucci(1), A Pacovich(1), ME Ibarra(1), E Cortez(1), P Velazquez(1), V
Chediack(1), ER Cunto(1)
(1) Muñiz.
Introducción: La pericarditis purulenta es una entidad
clínica poco frecuente en la era antibiótica (<1% de las pericarditis),
generalmente secundaria a foco contiguo o por diseminación hematógena. El
cuadro clínico es grave con tendencia al taponamiento cardiaco (40-70% de los
casos) y alta morbimortalidad. En la actualidad el agente etiológico
predominante es Staphylococcus aureus, menos frecuentemente el Streptococcus
pneumoniae.
Caso clínico: Hombre de 29 años, hombre, infección por VIH
de transmisión vertical sin tratamiento. Ingresa a terapia intensiva por shock
séptico e infección COVID-19 crítico, requiriendo ventilación mecánica y
vasopresores. Tomografía de tórax: imagen compatible con neumonía con derrame
pleural derecho, lesión cavitada izquierda y derrame pericárdico.
Ecocardiograma: derrame pericárdico grave con colapso derecho. Con diagnóstico
de taponamiento cardiaco, se realiza pericardiocentesis percutánea obteniéndose
liquido macroscópicamente purulento. Se inicia tratamiento antibiótico con
imipenem, vancomicina y amikacina. Ecocardiograma, 24 horas posteriores: leve
cantidad de líquido pericárdico, función sistólica conservada. Laboratorio:
Tabla 1. Bacteriología: liquido pericárdico y hemocultivos: Streptococcus
pneumoniae sensible penicilina, CIM: 0.25 µg/ ml. Se rota antibiótico a
ceftriaxona. Se retira drenaje pericárdico al dia 7 sin reproducción del
derrame. Intercurre con neumonía por Klebsiella pneumoniae, permanece aún
internado.
Discusión: El paciente presenta una pericarditis
purulenta por Streptococcus pneumoniae probablemente secundaria a la neumonía.
El ecocardiograma pocus realizado por el intensivista permitió el diagnostico
en tiempo real del taponamiento y rápido tratamiento.
La modalidad de drenaje pericardio optima no
está bien definida, se prefiere la opción quirúrgica (mejor drenaje y
disminución de evolución a pericarditis constrictiva).
Se debe descartar otras causas etiológicas
como Staphylococcus aureus, otros Streptococcus y bacterias de lento
crecimiento.
Conclusiones: La pericarditis purulenta es un cuadro
inusual en la actualidad, pero es importante su diagnóstico precoz debido a la
rápida evolución y tendencia al taponamiento pericárdico.
La mortalidad aun con tratamiento adecuado es
elevada (2-20%)
Ante un paciente con clínica de sepsis y con
imágenes sugestivas de derrame pericárdico se debe realizar pericardiocentesis
para descartar este diagnóstico.
No hemos encontrado en la literatura la
asociación de infección por VIH, SARS CoV-2 y pericarditis purulenta por
Streptococcus pneumoniae.

0330 INGESTA SUBREPTICIA DE
FUROSEMIDA: MANIFESTACIONES HIDROELECTROLITICAS Y DERMATOLOGICAS
DN Gauna(1), M
Daniel(1), F Benavente(1), MP Etchemendi(1), A Dubin(1)
(1) Sanatorio Otamendi.
Introducción: El consumo de altas dosis de furosemida ha
sido asociado a dano renal inflamatorio tanto agudo como crónico, siendo la
“Nefritis Tubulointersticial”, el hallazgo anatomopatologico típico (1). Mucho
menos conocida es la asociación del consumo de furosemida con lesiones cutáneas
inflamatorias y recurrentes que remedan a la Porfiria Cutánea Tarda (Pseudoporfiria)
(2).
Presentación de caso: Presentamos el caso de una paciente de 42
años con antecedentes de lesiones en piel (porfiria en estudio medicada con
corticoides), hipotiroidismo, depresión y caídas frecuentes, que ingresó al
Sanatorio por presentar debilidad muscular generalizada (progresiva en las
últimas 72 hs) e hipokalemia severa (K En un reinterrogatorio dirigido se
obtuvo información acerca de un consumo crónico de diuréticos sin prescripción
médica de hasta 500 mg/d de furosemida.
Discusión: En este reporte se exponen las distintas
manifestaciones clínicas e hidroelectrolíticas de la disfunción renal “tubular
y glomerular” del paciente probablemente debidas al consumo crónico de
furosemida: a) acidosis metabólica, hipo/hiperkalemia por compromiso de las
porciones tubulares distales del nefrón, b) incapacidad para concentrar la
orina secundaria a la afección de la médula renal y c) caída de la TFG por daño
glomerular.
Conclusión: La búsqueda de drogas (diuréticos en este
caso, tóxicos o laxantes entre otros) exhaustivo permitió avanzar con un
diagnóstico adecuado en un paciente con trastornos hidroelectroliticos diversos
y lesiones cutáneas que simulan una porfiria.
Referencias: 1) Park CW; Chronic tubulointerstitial
nephritis and distal renal tubular acidosis in a patient with frusemide abuse.
Nephrol Dial Transplant (2001) 16: 867-9.
2) Harber TL; Porphyria and Pseudoporphyria.
The Journal of Investigative Dehmatology, 82:207-209, 1984
L Corbalan(1), C
Vignetta(1)
(1) Hospital Municipal De Urgencias -
Córdoba.
Introducción: Las últimas evidencias científicas, podrían
revelar una asociación entre la progresión de las lesiones hemorrágicas
traumáticas y los bajos niveles de calcio de los pacientes que poseen estas
lesiones. El presente estudio busca analizar esta asociación; y si los niveles
bajos de calcio son un factor de riesgo en los cuadros coagulopaticos.
Material y métodos: Estudio retrospectivo, analítico. Incluyó
pacientes ingresados con diagnóstico de traumatismo de cráneo, con edades entre
16-70 años. Se recolectaron datos demográficos y de los asociados al trauma; se
registraron variables analíticas de laboratorio que hacen al estado de
coagulación, niveles de calcio iónico al ingreso y 6 horas del trauma, se
definieron tipo y volúmenes de lesiones hemorrágicas identificadas en
tomografía de cerebro de ingreso y control, se determinó si existió un aumento
de las mismas superior al 20%. La asociación entre las variables de estudio se
efectuó mediante la prueba Chi Cuadrado y se definió el Riesgo Relativo.
Resultados: Se analizaron 167 pacientes, de los cuales 94
cumplían con los criterios de selección. La hipocalcemia se presentó en un 67%
de los pacientes al ingreso y en un 51% en el control a las 6 horas. La
progresión de la lesión hemorrágica traumática (PLHT) estuvo en un 43%. No
existió una asociación estadísticamente significativa entre los niveles de Ca++
y la PLHT (significativa (X2 (1) = 0.45, p 0.5; V de Cramer de 0.022) (Imagen
A). Los estados de hipocalcemia se asociaron a un riesgo más elevado de
coagulopatía en estos pacientes (Odds Ratio 2.109 IC 95% 0.42 – 10.58) (Imagen
B).
Conclusión: Niveles de Ca++ menores a 1.1 mmol/l al
ingreso no se relacionaron con una progresión de las lesiones traumáticas
hemorrágicas cerebrales. Existe un riesgo aumentado en el desarrollo de
coagulopatía y niveles de Ca++ menores a 1.1 mmol/l, en las lesiones traumáticas
hemorrágicas cerebrales.


0332 ATURDIMIENTO MIOCARDIACO
NEUROGENICO EN UN PACIENTE CON SLPR. PRESENTACION DE UN CASO
M Martinez, LC
Avila(1), EC Rodriguez(1)
(1) Instituto Medico Rio Cuarto.
Introducción: El aturdimiento miocárdico neurogénico se
define como el daño y disfunción miocárdica en ausencia de enfermedad coronaria
y que ocurre posterior a una injuria cerebral aguda como resultado del
disbalance del sistema nervioso autónomo. Se puede presentar con cambios segmentarios
en la pared del ventrículo izquierdo y elevación de los biomarcadores
cardiacos, con recuperación ad integrum una vez resuelto el cuadro neurológico.
Presentamos un caso de aturdimiento
miocárdico neurogénico por síndrome de leucoencefalopatia posterior reversible
(SLPR).
Reporte de caso: Mujer de 33 años, hipotiroidea, ingresa por
status epiléptico refractario a drogas de primera y segunda línea, en uti
tratamiento con propofol, IOT y ARM, hemodinamicamente estable. A las 48hs,
shock cardiogenico.
Lab: troponina: 4.12, cpk:304, cpk-mb:28,
mioglobina: 31.3, acidosis metabólica hiperlactacidemica, ac lact: 2.5, gb:
23.700. PL: s/p
RMN cerebro: Imágenes hiperintensas en T2 y
flair en sustancia blanca profunda, periventricular y en centro semiovales,
sugestivas de leucoencefalopatia posterior reversible.
Ecocardiograma:-diámetros y espesores
conservados.-hipomotilidad global, a predominio septal y anterior con función
sistólica disminuida (fey:37%).-insuficiencia mitral leve.-disfunción diastólica
del vi grado I.
ECG:taquicardia sinusal con trastornos de la
reporalizacion inespecífico.
Dia 9: estabilidad hemodinámica, extubacion,
sin signos de foco neurológico.
Ecocardiograma:-función sistólica global
conservada.-disfunción diastólica del vi grado I.-fey:69%.
Día 11 alta sanatorial.
Discusión: La etiopatogenia del aturdimiento miocárdico
neurogénico no está clara y podría obedecer a un fenómeno de isquemia
miocárdica, con un fenómeno posterior de reperfusión, que produce liberación de
radicales libres y activación de la cascada inflamatoria, que ocasiona una
cardiomiodepresión o un fenómeno de citotoxicidad cardíaca directa.
La sospecha de una disfunción miocárdica en
el contexto de paciente neurocritico, supone la necesidad de realizar un diagnóstico
diferencial con: miocarditis, síndrome coronario agudo, takotsubo.
Conclusión: La disfunción miocárdica neurogénica es una
patología infradiagnosticada en la práctica y que debe ser pensada como posible
complicación en todos los pacientes neurocriticos. Su rápida instauración y
desmejoria del paciente suman una alta morbimortalidad en ellos y puede ser
minimizado con su diagnóstico oportuno que podemos realizar al incorporar la
ecocardiografía realizada por los intensivistas a la cabecera de la cama de los
pacientes.


0333 MANEJO DE ESTENOSIS
TRAQUEAL EN PACIENTES COVID-19
M Singh(1), F Am(1), J
Moreno(1)
(1) Sanatorio San Roque.
Introducción: La estenosis traqueal es consecuencia de un
proceso producido por isquemia de la mucosa con cicatrización anormal que
general distintos grados de obstrucción de via aérea. Es razonable pensar que
los pacientes con Sindrome de Distres Respiratorio asociado a COVID19 pueden
presentar mayor predisposición a estenosis traqueal porque requieren largos
periodos de intubación y porque presentan múltiples comorbilidades con marcada
tendencia a la inflamación tisular. El tratamiento suele ser controvertido e
implica un trabajo multidisciplinario
Caso clínico: Paciente femenino de 36 antecedentes de
diabetes tipo I, Hipertensión, Enfermedad Renal Crónica en Hemodiálisis,
ingresa cursando neumonía bilateral por covid-19 con requerimiento de ARM con
adecuada evolución se realiza extubación programada al 7mo día. Al 4 día
postextubación, presenta disfonía, disnea súbita, tiraje, taquipnea, se
constata por otorrinolaringologia parálisis de cuerdas vocales, se solicita Rx
de cuello que constata estenosis traqueal severa circunferencial. Paciente
evoluciona con requerimiento de ARM con tubo N5. Se realiza Laringoscopia
directa, broncosopia, traqueoscopia directa terapéutica con extracción de
granulomas y dilatación traqueal e intubación con tubo N7. Se realiza
tratamiento con corticoides por 72 hs y extubación programada. Paciente con
adecuada evolución actualmente bajo tratamiento con fonoaudiología.
Discusión: La estenosis laringotraqueal posterior a
procedimientos como intubación prolongada en genera es más frecuente en
pacientes con múltiples patologías. Se calcula que se produce en
aproximadamente el 5-20% de los pacientes intubados o traqueostomizados. Un 1%
de los casos conllevan disfunción respiratoria severa. El COVID-19 está
estrechamente relacionado con síndrome de respuesta inflamatoria sistémica,
falla orgánica y sepsis; aumentando la mortalidad y la probabilidad de producir
estenosis traqueal independiente del periodo que dure el procedimiento.
Conclusión: El síndrome insuficiencia respiratoria por
estenosis traqueal es una entidad poco frecuente, condicionada por enfermedades
de base y patologías proinflamatorias. El tratamiento depende de la
presentación clínica, si es una emergencia o no y el aspecto de la lesión. La
broncoscopia terapéutica ha modificado de forma sustancial el manejo de este
tipo de enfermedades, y llega a desplazar a la cirugía en determinados casos.
En combinación con un tratamiento médico farmacológico. Es necesario realizar
prevención para evitar un desenlace fatal.


0334 TERAPIA DE REEMPLAZO RENAL
CONTINUA DE PACIENTES CRITICOS EN PANDEMIA
R Gregori
Sabelli(1), C Dominguez(1), Y Lamberto(1), P Saul(1), V Fernandez Abello(1), J
Fernandez(1), A Bocassi(1), E Cortez(1), L Doldan(1), O Ortuño Cerezo(1), S
Caceres(1), C Vargas(1), N Chacon(1), V Chediack(1), E Cunto(1)
(1) Muñiz.
Introducción: La lesión renal aguda (LRA) es una
complicación grave y frecuente en la terapia intensiva (TI). Las terapias de
reemplazo renal continuas (TRRC) son utilizadas hasta en un 10% en el paciente
crítico.
Objetivos: Analizar el impacto en la mortalidad en el
inicio de TRRC en base a la duración de la oliguria en pacientes críticos COVID
-19 positivo (COV+) y negativo (COV -)
Material y Método: Estudio observacional, descriptivo,
retrospectivo, caso-control. Se evaluaron 43 pacientes críticos (enero 2021/
julio 2022) con lesión renal aguda según clasificación KDIGO con indicación de
TRRC.
N=43, 18 pacientes COV + / 25 pacientes COV -
La estadística descriptiva usó porcentaje
(%), media (M), rango (mínimo-máximo).
Se evaluó la relación entre el inicio de TRRC
en base a la duración de la oliguria (≤ o > a 24 horas), evolución
desfavorable y mortalidad mediante prueba de Chi2. Se consideró significativo
una p ≤ 0,05, se evaluó Odds ratio (OR) e IC95%.
Resultados:
Pacientes COV +
Con TRRC n= 18 (hombres 16). Edad (M) 60
(35-77) años. Ventilación mecánica (VM) 17 pacientes (94%). Óbito 14 pacientes
(77%). El inicio de TRRC con oliguria ≤ 24 horas 10 pacientes (55%) y con >
de 24 horas 8 pacientes (44%).
Pacientes COV –
Con TRRC n= 25 (varones 19). Edad (M) 47 años
(23-93 años), VM 19 pacientes (76%). Óbito 13 pacientes (48%).
El inicio de TRRC con oliguria ≤ 24 horas 14
pacientes (56%) y > 24 horas 11 pacientes (44%).
La mortalidad global de los pacientes con
TRRC dentro de las 24 horas de desarrollada la oliguria fue de 40% (11
pacientes) cuando se inició luego de las 24 horas fue de 64% (16 pacientes)
OR=0,16 IC 0,03-0,69 p 0,02. Comparando pacientes COV + y COV - no se evidenció
p significativa en relación al inicio temprano de TRRC y mortalidad.
Conclusiones: Nuestra experiencia en el inicio de TRRC ≤ a
24 horas de oliguria podría resultar beneficioso ya que evidenció menor
mortalidad.
En la literatura publicada la asociación
COVID-19 y LRA es un factor predictor importante de progresión a VM y
mortalidad, en nuestra serie este hecho no fue estadísticamente significativo.
![]()

0335 Donación en asistolia
controlada en un hospital público de Argentina. Serie de casos
MR Domanico(1), DA
Rodriguez(1), E Duarte(1), P Centeno(1), M Anchorena(1), M Petre(1), X
Benavente(1), J ángulo(1), R Canelon(1), D Ortega Rodriguez(1), E Montiel(1), G
Duca
(1) Hospital De Alta Complejidad Del
Bicentenario De Esteban Echeverría.
Introducción: La disponibilidad de órganos para trasplante
es una problemática en Argentina. En Estados Unidos la donación en asistolia
(DA) representa el 10% de todos los donantes, mientras que en Argentina esta
modalidad es escasa y muchas veces desconocida. El objetivo del presente
estudio es describir una serie de cinco donantes renales bajo un programa de
donación en asistolia controlada (DAC) Maastricht III. Secundariamente
describir el seguimiento a corto plazo de los receptores.
Materiales y métodos: Estudio observacional, descriptivo de tipo
serie de casos llevado a cabo en el Hospital de Alta complejidad del
Bicentenario Esteban Echeverría. Los datos se recolectaron del Sistema Nacional
de Información de Procuración y Trasplante de la República Argentina (SINTRA) y
de la historia clínica electrónica de la institución. Se incluyeron donantes
renales bajo un programa DAC Maastricht III (ver Figura 1) entre Julio
de 2021 y Agosto de 2022. Se describen variables clínico-demográficas y de
resultado tanto de los donantes como de los receptores. Se realizó un análisis
estadístico de tipo descriptivo.
Resultados: Cumplieron los criterios de elegibilidad 5
donantes de los cuales 4 fueron efectivos. Siete pacientes recibieron
trasplante renal. En la tabla 1 se encuentran las características
clínico-demográficas y de resultados de los donantes y receptores.
Conclusión: Se describió una serie de cinco casos de
donantes renales bajo asistolia controlada lo que evidencia que la misma es una
estrategia posible para el trasplante en la Argentina. A su vez se describió el
seguimiento a corto plazo de los pacientes trasplantados.


LC Avila(1), M
Martinez(1), G Abrile(1), E Rodriguez(1)
(1) Instituto Medico Rio Cuarto.
Introducción: La pileflebitis es la trombosis séptica de la
vena porta o sus ramas, por procesos infecciosos intraabdominales en su área de
drenaje.
Al diagnóstico se llega por sospecha clínica
y pruebas de imagen, principalmente TAC. La complicación deriva de la trombosis
y la diseminación de émbolos sépticos que llevan a isquemias y abscesos de sus
afluentes, entorpeciendo la evolución clínica. Es una complicación infrecuente
con elevada tasa de morbimortalidad.
Presentación del caso: Paciente masculino de 66 años, HTA, obeso,
presenta 9 días de dolor abdominal y fiebre. TAC de abdomen apendicitis
gangrenosa con alteración de los planos grasos adyacentes y engrosamiento de la
fascia parietocolica. Se realiza Apendicectomia
Día 3 pop continua con dolor en flanco y FID,
equimosis en pared abdominal, en TAC se observa: hemoperitoneo perihepatico,
esplenomegalia con infarto esplénico.
Día 5: febril persistente, nueva TAC:
trombosis parcial de la vena porta y completa de la mesentérica superior,
liquido libre en espacio de Morrison. Se realiza laparoscopia terapéutica +
oomentectomia con aspiración de sangre y coágulos. Se inicia con enoxaparina
anticoagulante.
Día 7: evoluciona torpidamente con falla
respiratoria y SIRSS, por lo que se decide ingreso a UTI. EAB: 7.45, 30.2,
57.1, 20.6, -2.6, 90.6. APACHE II: 13, SOFA: 3. Hemocultivos y urocultivo.
Se rotan atb.
Resultados de cultivos negativos
Luego de 13 días de internación se decide
alta sanatorial, continuando con anticoagulación y antibióticos.
Discusión: La pileflebitis es un proceso infeccioso
intraabdominal, sus causas principales son diverticulitis aguda y apendicitis.
El proceso infeccioso se extiende a través de ramas mesentéricas periféricas
alterando el endotelio vascular y provocando la aparición de trombosis. Si el
proceso supurativo se extiende se forman abscesos.
Conclusión: Es una complicación a contemplar que puede
empeorar la evolución del paciente, es necesario implementar imágenes para
alcanzar un diagnóstico. El tratamiento consiste en antibioticoterapia de
amplio espectro durante un mínimo de 4 semanas. La anticoagulacion es
controvertida, siendo recomendable ante pileflebitis extensa, como en este
caso, con oclusión venosa mesentérica.


0338 TROMBOSIS VENOSA CEREBRAL
UN RETO DIAGNÓSTICO Y TERAPÉUTICO. REPORTE DE CASO
CSA Cieri(1), C
Lopez(1), M Vera(1), D Aldunate(1), G Chiarolla(1), S Santarelli(1), G
Fernandez(1), H Vitale(1), A Ontiveros(1), A Sabrina(1)
(1) Hospital Central.
Introducción: La trombosis venosa cerebral representa el
0,5% al 1% de los ACV según bibliografía consultada. Afecta con mayor
frecuencia a jóvenes con factores de riesgo congénitos o adquiridos. Se
presenta con crisis convulsivas, cefalea, signos de foco neurológico y
papiledema. El diagnóstico se confirma con Angio Tomografía axial computarizada
(TAC) y Resonancia magnética nuclear (RMN) cerebral. El pronóstico suele ser
bueno en cuanto a morbimortalidad
Caso clínico: Femenino. 45 años. Antecedentes: Trombosis
venosa profunda miembro superior derecho 2011. Padre: síndrome
antifosfolipídico. Hermano: trombofilia. Consulta en guardia por Cefalea holocraneana
de 96hs y afasia de expresión. TAC de cerebro sin lesiones, punción lumbar sin
particularidades. Agrega hemiplejia Facio-baquio crural derecha y convulsión.
Glasgow 10/15. AngioTAC: Hematoma cortico-subcortical frontal izquierdo con
hipo densidad de sustancia blanca peri-lesional. Serie venosa: defecto de
llenado en topografía del sector medio del seno sagital superior, compatible
con trombosis venosa confirmada por Angio- RMN. Laboratorio: Déficit de
proteína S. Diagnóstico: Trombosis de seno sagital superior, infarto venoso con
transformación hemorrágica, en contexto de déficit de Proteína S. Inicia
anticoagulación, medidas anti-edema cerebral. Evoluciona favorablemente.
Discusión: De acuerdo con el Estudio Internacional sobre
Trombosis Venosa Cerebral y de senos durales (ISCVT) el 34% de los casos tenían
enfermedad protrombotica adquirida o hereditaria. Se recomiendan angiografía
por sustracción digital y venografía por Tomografía como alternativas a la
Venografía por Resonancia Magnética (Gold Standard) con nivel de evidencia
bajo. El tratamiento se basa en Anticoagulación (IIAB).
Las trombofilias hereditarias, presentan
eventos recurrentes en ausencia de anticoagulación; 19 % a los 2 años, 40 % a
los 5 años y 55 % a los 10 años. Para pacientes con Trombosis venosa cerebral
recurrente o primer evento con trombofilia grave, se puede considerar la
anticoagulación indefinida con un RIN objetivo de 2 a 3 (C IIB).
Conclusión: Debido a la baja incidencia, diversidad de
factores de riesgo y formas de presentación, sumado a la escasez bibliográfica;
se debe sospechar esta patología en mujeres jóvenes con sintomatología
neurológica aguda, para lograr diagnóstico y tratamiento temprano.


0339 TRASPLANTE HEPATICO (TxH)
EN HÍGADO GRASO AGUDO DEL EMBARAZO (AFLP). REPORTE DE CASO
F Molina(1), L
Perez(1), L Ojeda(1), L Haddad(1), M Acebo(1), D Otalora(1), G Tuhay(1), C
Ballesteros(1), G Pantoja(1), F Klein(1)
(1) Fundacion Favaloro.
Introducción: El hígado graso agudo del embarazo (AFLP) es
una enfermedad rara que se presenta durante el tercer trimestre de gestación.
Su prevalencia es 1/10.000-15.000 nacimientos. La mortalidad reportada es de
20%. En raras ocasiones se presenta Insuficiencia Hepática Aguda (IHA).
Reporte de caso: Paciente de 25 años G1P1A0C0. El día1 ingresó a
otra institución, en trabajo de parto con embarazo 34 semanas, evolucionando
con IHA (Ver Tabla 1) agregando deterioro del sensorio en 24 horas. El día 2
fue derivada a nuestra institución, bajo requerimiento de vasopresores,
intubada, evolucionando con disfunción multiorgánica (Hepática, renal,
hematológica, hemodinámica, neurológica, Score APACHEII 26/35%). Con
diagnóstico de IHA, cumpliendo criterios Kings College no paracetamol se evalúa
y coloca en lista de espera en emergencia para TxH. Durante el monitoreo neuro
intensivo se realizó eco doppler transcraneal con un índice 1,6 y un diámetro
de la vaina del nervio óptico: 6.5mm, TAC encéfalo sin sangrado, con medición
inicial de cateter de PIC: 9mmHg (Intraparenquimatoso). El día 3 se realizó
trasplante hepático técnica Piggy-Back, evolucionando con PIC: mayores a 30mmHg
por más de 5 minutos, con imágenes compatibles con leuco encefalopatía
posterior reversible (PRES) (Ver figura 1), indicándose craniectomía
descompresiva bifrontal (Durotomia de descarga superficial), controlando
hipertensión endocraneana (HTE). El día 5 ante buena evolución clínica se
extuba y retira cateter de PIC, pasando el día 9 a sala general, con posterior
egreso el día 20.
Discusión: El AFLP es una patología poco frecuente que
generalmente resuelve tras el parto. En nuestro caso, evoluciono con IHA y sus
complicaciones, siendo la más grave el edema cerebral e HTE. Se confirmó el
diagnostico con estudio anatomopatológico de órgano trasplantado de AFLP (Ver
figura 1).
Conclusión: En el AFPL con IHA resulta imprescindible
disponer de la opción terapéutica del TxH. La descripción de evolución del caso
enfatiza la necesidad de apelar al monitoreo neurointensivo multimodal para el
manejo pretrasplante y el seguimiento de sus complicaciones.


0340 SINDROME DE
HIPERVISCOSIDAD EN PACIENTE CON
MACROGLOBULINEMIA DE WALDESTROM
A Gira(1), F
Monsalve(1), R Almanza(1), A Perez De Andes(1), C Steer(1), P Pratesi(1), G
Mast(1)
(1) Universitario Austral.
Introducción: El Sindrome de hiperviscodad caracterizado
por tríada clásica: sangrado y alteraciones visuales y neurológicas asociado a
valores de Inmunoglobulinas >6000 mg/dl. Su incidencia en pacientes con
Macroglobulinemia de Walsdestrom es del 14%.
La viscosidad sanguínea normal es <1,5 mPa
con > 4 MPa aparecen sintomas. No se debería solicitar medición de
viscosidad con Inmunoglobulinas < 4000 mg/dl.
La viscosidad es mayor en vénulas provocando
sangrados: epistaxis, gingivorragia, hemorragias retinianas y el estancamiento
de sangre en vénulas cocleares provoca pérdida auditiva y síntomas vestibulares
y somnolencia, convulsiones, ataxia y coma.
Uso de plasmaferesis, Una sesión puede
reducir Inmunoglobulinas hasta un 60%. Su indicación se basa más en los signos
y síntomas. Es útil medir niveles de proteínas antes y después de cada sesión
Reporte de caso: Masculino de 64 años, ante decentes de
Síndrome Mielo proliferativo, Macroglobulinemia de Waldestrom : 2 meses previos
presenta hipercalcemia e IgM 8460 mg/dl con fondo de ojo normal, realiza
corticoterapia mas hidratación.
Ingresa por guardia por fiebre y dolor en
sitio de punción (PBMO 48 hs previas), se realiza RM de pelvis con edema en TCS
, IgM 7910 mg/dl inicia antimicrobianos, ingresa a UCI por Insuficiencia
ventilatoria, coagulopatia y falla renal e Hipoacusia bilateral súbita más
somnolencia, fondo de ojo con hemorragias en llama, realiza 4 sesiones de
plasmaferesis, curva diaria de IgM: 9460, 7910, 5340, 4617,3880 mg/dl revierte
síntomas y pasa a clínica médica.
Discusión: En nuestro caso el paciente presento clínica
y laboratorio compatible con síndrome de hiperviscosidad y posterior a la 4
sesion de plasmaferesis revierte en forma completa los síntomas, se realizo
curva de dosaje de IgM y no se solicitó medición de Viscosidad sanguínea
Conclusión: Si bien el diagnóstico es determinado por la
medición de la viscosidad sanguínea, la decisión de iniciar un tratamiento se
basa en la clínica del paciente. Se trata de una emergencia médica y el
tratamiento con plasmaféresis deber ser iniciado lo antes posible.
J Bernachea(1), V
Giménez(1), L Gamarra(1), J Martinez(1), L Ojeda(1), C Mizdraji(1), S
Lazzeri(1), E Alfonso(1), H álvarez(1), L Costa(1), C Pisarello(1), L
Huespe(1), K Velazco(1), L Solis(1), M Gonzalez
(1) Hospital Escuela General Jose Francisco
De San Martin.
Introducción: La Ultrasonografía y el concepto POCUS, se ha
convertido en una de las herramientas diagnósticas, siendo importante para la
valoración hemodinámica en los pacientes críticos.
Presentación del caso: Paciente femenina de 67 años, hipertensa. El
día 20/08/22 ingresa en emergencias por trastorno del sensorio (GSC 12/15).
Signos vitales: TA 100/80, FC 53, FR 17, SatO2 97%. Se realiza TC de cerebro
que evidencia lesión hipodensa en territorio de arteria cerebral media, y TC de
tórax que evidencia derrame pericárdico. Evoluciona posteriormente con
deterioro neurológico (GSC 3/15), secundario a inestabilidad hemodinámica (TA
70/40 mmHg), por lo que se decide su intubación y reanimación con fluidos.
Ingresa a UCI bajo analgosedación, presentando signos clínicos de hipoperfusión
(palidez cutánea, relleno capilar > 4 segundos, pulsos periféricos
irregulares). Se aplica Protocolo RUSH por sospecha de taponamiento cardíaco,
observándose derrame pericárdico moderado, sin colapso de cavidades derecha y
desvío del tabique interventricular, con evidencia latidos asincrónicos. Se
realiza ECG que informa ritmo irregular sin evidencia de ondas P. Se asume como
fibrilación auricular de alta respuesta ventricular. Se inicia cardioversión
farmacológica con dosis de carga y mantenimiento de amiodarona, revirtiendo a
ritmo sinusal, con posterior estabilidad hemodinámica. El día 21/08/22 se
extuba, siendo dada de alta el 22/08/22.
Discusión: La utilidad del ultrasonido rápido para shock
en las UCI ha sido ampliamente demostrada.
Conclusión: Nuestro caso permite destacar Importancia de
la ultrasonografía para el manejo de la inestabilidad hemodinámica en el
paciente critico.


G Rodriguez(1), N
Palacios(1), M Lamas(1), P Balceda(1), V Gallardo(1), G Cruz(1), M Balceda(1),
P Baez(1), O Lopez(1), V Limon(1), C Tintilay(1), D Sajama(1), D Crespo(1)
(1) Pablo Soria.
Introducción: Como Personal de Salud, nos encontramos con
personas en diferentes situaciones vulnerables, y esto aumenta si el paciente
es ingresado en la Unidad de Terapia Intensiva. Brindamos cuidados específicos
de acuerdo a la patología del paciente, en ocasiones dejamos en segundo plano
su cuidado integral, esto incluye el adecuado aporte nutricional. El paciente
crítico suele presentar una respuesta inflamatoria exacerbada posterior a un
daño, que lo conduce a una situación de estrés metabólico acompañada de un
catabolismo proteico, como sabemos el hipercatabolismo producen modificaciones
importantes en el requerimiento energético del paciente, dejando como resultado
potenciales riesgos de adquirir complicaciones.
El deterioro nutricional que sufren los
pacientes críticos va más allá de su estado nutricional previa a su admisión y
el deterioro es más pronunciado en pacientes con falla multiorgánica. Además,
existen factores intrínsecos como extrínsecos que inciden en su desnutrición,
como el aporte nutricional limitado por su inestabilidad hemodinámica,
patologías que alteren su estado nutricional actual, o por presentar
interrupciones frecuentes en la administración disminuyendo el aporte calórico.
Al ser profesionales de la salud con
capacidad ética, científica y técnica debemos brindar un aporte nutricional
adecuado, oportuno y eficaz. Valorando, vigilando y previniendo posibles
complicaciones metabólicas; infecciosas; mecánicas y gastrointestinales.
Objetivos: Implementar estrategias útiles y eficaces
para que el paciente logre recibir soporte nutricional suficiente, en cuanto a
valor calórico y proteico, durante su internación.
Método: Se realizó un estudio de diseño descriptivo
cuantitativo durante seis meses, la muestra fue consecutiva.
Material: Registro de observación al personal de
enfermería en la implementación de la herramienta de monitoreo en la
administración de alimentación enteral
Conclusión: Este trabajo nos permitió elaborar e implementar
herramientas de monitoreo de las cuales se obtuvieron datos
específicos/relevantes. Y la capacitación del personal de enfermería sobre la
importancia del aporte total calórico-proteico en el paciente, los cuales
tuvieron una adherencia progresiva como también se vio reflejado la
administración adecuada y requerida en cada caso, logrando alcanzar el aporte
calórico previamente establecido por los Nutricionistas.

0345 SÍNDROME NEUROLÉPTICO
MALIGNO. REPORTE DE CASO CLÍNICO
L Ruarte(1), L
Morales(1), M Garcia(1), P Taborda(1), J Ortega(1), A Quinteros(1), S Rojas(1),
C Ferreyra(1), D Carranza(1), N Bonetto(1), S Carrizo(1), J Celia(1), M
Ruiz(1), M Buemo(1)
(1) Regional Victor Sanguinetti.
Introducción: El Síndrome Neuroléptico Maligno (SNM) es una
urgencia médica de baja incidencia, asociado al uso de fármacos antipsicóticos
principalmente. Se manifiesta con hipertermia, trastornos autonómicos,
alteración muscular y del estado de conciencia. Sin tratamiento la mortalidad
es del 4-10%.
Presentación del caso: Masculino de 20 años, con diagnóstico de TEC
grave con hematoma extradural, ingresa UTI postdrenaje quirúrgico. Evoluciona
favorablemente pero intercurre con delirio activo durante el proceso de
weaning, se inicia haloperidol 40 mg/día, con escasa respuesta incrementándose
hasta dosis 60 mg/día. Se extuba sin complicaciones; paciente se mantiene con
Glasgow 14/15,alternando episodios de excitación psicomotriz y síndrome
confusional, por lo que se asocia clorpromazina50 mg día por 24hs. Al quinto
día de internación presenta fiebre, se cultiva e inicia ATB empírico cubriendo
foco meníngeo y respiratorio. Sin rescate de gérmen en cultivos. Evoluciona con
rigidez muscular, mioclonías, fiebre persistente hasta 41°C e incremento de transaminasas
y CPK. Requiere reintubación por deterioro del sensorio. Con diagnóstico
presuntivo de nueva infección, disautonomía y status convulsivo, se suspende
neuroléptico, se modifica esquema ATB y se instaura tratamiento anticomicial
sin respuesta. Se plantea como diagnóstico presuntivo Síndrome Neuroléptico
Maligno, iniciando tratamiento con dantroleno y amantadina. Mejora
paulatinamente los síntomas a las 48hs, se mantiene afebril, recupera status
neurológico, logrando su extubación luego de 4 días.
Discusión: La baja incidencia pero alta mortalidad de
este síndrome, hacen pertinente la sospecha del mismo sobre la base de los
hallazgos clínicos. Las manifestaciones tempranas, tales como los cambios del
estado mental, pueden pasar desapercibidas. Deberán considerarse factores
predisponentes como sexo masculino, condición fisiológica previa y fármacos
empleados. También evaluar estudios complementarios que orienten el diagnóstico
y descartar otras patologías.
Conclusión: Se estableció diagnóstico de SNM secundario a
la administración de neurolépticos por clínica y la respuesta al tratamiento
insaturado. El abordaje temprano del síndrome y la intervención oportuna con
medidas de sostén y farmacológicas fue determinante para la resolución,
evitando complicaciones que pudieran comprometer la vida. Así mismo, nos
permitió desarrollar un protocolo de la patología para nuestra unidad, y
revisar el uso de estos fármacos.
0346 EVOLUCIÓN DE PACIENTES
TRAQUEOSTOMIZADOS COVID Y NO COVID
F Amieva(1), G Ramos(1),
V Picolla(2), R Fiorentino(1), N Arias(1), A Carusso(1), A Enrique(1), R
Mattei(1), E Soler(1), M Ducassa(1), M Salazar(1), B Paula(1), B Melanie(1), C
Carlos(1)
(1) Cosme Argerich. (2) Cosme Argericg.
Introducción: La traqueostomía es una importante
intervención terapéutica en terapia intensiva, especialmente para pacientes con
requerimiento de asistencia respiratoria prolongada. La pandemia por COVID-19
supuso un desafío por el incremento de pacientes con requerimiento de este
procedimiento y los riesgos asociados a los mismos. Realizamos el estudio en la
segunda ola de la pandemia en la que se estandarizó el protocolo, de manera de
poder comparar los resultados entre pacientes COVID y no-COVID.
Materiales y métodos: Estudio retrospectivo de pacientes
traqueostomizados en terapia intensiva (12 meses) en el período 2021-2022
(Junio-Mayo). Se subdividieron en 2 grupos: COVID y no-COVID.
Se consideró significativa una P < 0.05.
Presentación del caso: Durante el periodo analizado ingresaron 602 pacientes.
El 53.1% (302) requirieron ARM y el 14.8% (89) traqueostomía. El 30.3%(27)
correspondiente a pacientes COVID y 69.6% (62) a pacientes con otras
patologías. El 41% (27) de los COVID en ARM requirió TQT vs 24.9% (62) de los
no-COVID (p <0.01). No hubo diferencias de edad y género entre ambos grupos.
La edad avanzada se asoció con mayor mortalidad (48.6 ±15.4 vs 61.3 ±15.1 años,
p<0.01). La traqueostomía más temprana en los no-COVID se asoció a menor
mortalidad (14.7 ±5.7 vs 17.4 ±4.5, p=0.02).Fueron externados y decanulados 22%
(6) vs 27.4 (17), desvinculados no decanulados 7.4% (2) vs 27.4% (17), en COVID
y no-COVID respectivamente. La desvinculación de ARM fue 29.6% (8) en COVID y
54% (34) en no-COVID (p 0.02).
Discusión: El porcentaje de pacientes en ARM que
requirieron traqueostomía (15%) fue similar a la reportada en la bibliografía,
pero significativamente mayor en el grupo de pacientes Covid (41%). La
traqueostomía más temprana en pacientes no-COVID significó un porcentaje mayor
de desvinculación del respirador y de decanulación (22%). Pudiendo estar
relacionado con la mas lenta resolución de la afección respiratoria y por lo
tanto a la debilidad adquirida durante la asistencia ventilatoria. La
mortalidad global fue del 47%, siendo mayor en el grupo COVID sin diferencia
significativa. La edad avanzada se asoció significativamente a mayor
mortalidad.
Conclusión: Los pacientes con insuficiencia respiratoria
por COVID tuvieron mayor requerimiento de traqueostomías, mayor mortalidad y
dependencia a la asistencia respiratoria mecánica.
0347 DISECCIÓN DE ARTERIA
PULMONAR ASOCIADO A FIBROSIS PULMONAR IDIOPATICA
M Singh(1), F Am(1),
J Moreno(1), R Santillan(1), S Gerez(1), DA Mariana(1), N Orosco(1), F
Enriquez(1), L Panozo(1), A Jove(1), J Salvadores(1)
(1) Sanatorio San Roque.
Introducción: La disección de arteria pulmonar es una
complicación extremadamente rara y generalmente letal asociada a la
hipertensión pulmonar crónica. Según Senbaklavaci el primer caso clínico fue presentado
post-mortem en 1862 por Walshe. Generalmente se diagnostica en un examen post
mortem, sin embargo, informes aislados recientes han descrito disección de la
arteria pulmonar en pacientes sobrevivientes que presentaban solo dolor
torácico disnea.
Caso clínico: Paciente masculino de 81 años, antecedentes:
Fibrosis pulmonar idiopática diagnosticada en 2021 agosto, en tratamiento con
Pirfenidona 850 mg dia ingresa cursando disnea progresiva GIV, astenia
sudoración profusa, malestar general cursando neumonía bilateral con
requerimiento de ARM/VNI con adecuada evolución se realiza tratamiento
antibiótico empírico para Neumonía de Comunidad, al 3 dia de internación con
mejoría clínica en plan de pase a sala. El 4to día de internación en Terapia
Intensiva evoluciona con descompensación súbita requerimiento de ARM/VNI se
realiza AngioTAC donde se observa disección de la rama ascendente y descendente
correspondientes a la arteria pulmonar izquierda (arteria lobar superior y
arteria lobar inferior izquierda). Paciente en plan de ingreso a hemodinamia
fallece posterior al diagnóstico.
Discusión: La disección de la arteria pulmonar se
considera una entidad rara con una mortalidad muy elevada. Las principales
causas subyacentes son hipertensión pulmonar y las cardiopatías, tanto
congénitas como adquiridas. Las presentaciones clínicas más frecuentes son
disnea y dolor torácico. En este caso la fibrosis pulmonar idiopática
desencadena hipertensión pulmonar severa que asociada a insuficiencia
respiratoria que se manifiesta como shock cardiogenico produciendo el deceso
del paciente.
Conclusión: La disección de la arteria pulmonar es un
suceso raro que se presenta por igual en ambos sexos con un rango etario amplio
con un pico de incidencia entre la cuarta y séptima década de la vida. Las
causas pueden ser múltiples como cardiopatías congénitas en los jóvenes,
mientras que en la edad avanzada las enfermedades respiratorias, inflamatorias
como autoinmunes pueden producir la disección. Dentro de las manifestaciones
clínicas más frecuentes se encuentra el dolor precordial y la disnea. El
tratamiento debe individualizarse según el paciente pudiendo requerir
tratamiento medico, reconstrucción quirúrgica o trasplante cardiopulmonar, con
una alta mortalidad.


A Feldman(1), J
Aguirre(1), C Lopez(1), D Varela(1), M Aliaga(1), S Tomez(1), B Daglio(1), M
Lompinzano(1), S Fredes(1), N Tiribelli(1), D Quaranta(1)
(1) Churruca.
Introducción: La enfermedad por (COVID-19), ha causado una
pandemia mundial con más de 6,7 millones infecciones y 390 000 muertes al 5 de
junio de 2020.
Objetivo: Describir la epidemiología de los pacientes
ingresados a la Unidad de Terapia Intensiva con diagnóstico de neumonía por
COVID-19.
Material y métodos: Estudio descriptivo,
retrospectivo y observacional de pacientes >15 años de edad ingresados a UTI
con diagnóstico de COVID-19 confirmado por RT-PCR desde enero del 2021 hasta
agosto del 2021.Las variables registradas: edad, sexo, escores de gravedad,
síntomas, fallas orgánicas, ventilación mecánica (VM), días de estadía y
mortalidad. Los datos se presentan como media ± DE, mediana + RI y porcentajes
%.
Resultados: Ingresaron a UTI 190 pacientes con neumonía
con COVID-19. Requirieron ARM 155 (81 %) por más de 24 hs, de los cuales 56
(36%) requirieron tocilizumab. La edad fue de 64±12 y el 68 % hombres. El
APACHE II 14±8 con riesgo de mortalidad del 53 %, el SOFA 4 ± 2. Los síntomas
fueron: fiebre 129 (68%), tos 123 (65%), disnea 40 (21%). Los factores de
riesgo HTA 80 (42%), obesidad 74 (39%), diabetes 38 (20 %), EPOC 8 (4%). Al
ingreso se observó shock en el 133 (70 %) y 165 (87 %) desarrollo SDRA. De los
45 pacientes que no requirieron ARM, 12 (22%) recibieron cánula de alto flujo
(CAF) y mascara reservorio 23 (43%). Se realizaron traqueostomías percutáneas
(TQTP) 91 (48%) pacientes, días a TQTP 15 [RI 8-20]. La PAFI de ingreso 112
[110-180], decúbito prono 114 [60%]. Complicaciones: shock séptico 114 (60%),
fallo renal 38 (20%), neumotórax 19 (10%), fistula traqueo-esofágica 3 (6%).
Los días de VM 12 [RI 8-15] y días de estadía en UTI 16 [9-20], la mortalidad
global fue del 58 % y la mortalidad en pacientes con tocilizumab fue de 48 %
(p=menor a 0.05).
Conclusión: Nuestra población muestra predominio en
pacientes en edad media y sexo masculino, con scores de gravedad elevados. La
mortalidad observada en pacientes que recibieron tocilizumab fue más baja.
A Feldman(1), J
Aguirre(1), C Lopez(1), D Varela(1), M Aliaga(1), S Tomez(1), B Daglio(1), M
Lompinzano(1), S Fredes(1), N Tiribelli(1), C Benay(1), D Quaranta(1)
(1) Churruca.
Introducción: El tocilizumab es un anticuerpo monoclonal
capaz de bloquear el efecto de la interleucina (IL) 6
Objetivo: Describir la epidemiología de los
pacientes ingresados a la Unidad de Terapia Intensiva con diagnóstico de
neumonía por COVID-19 que requirieron Tocilizumab
Material y métodos: Estudio descriptivo, retrospectivo y
observacional de pacientes >15 años de edad ingresados a UTI con diagnóstico
de COVID-19 confirmado por RT-PCR desde enero del 2021 hasta agosto del
2021.Las variables registradas: edad, sexo, escores de gravedad, síntomas,
fallas orgánicas, ventilación mecánica (VM), días de estadía y mortalidad. Los
datos se presentan como media ± DE, mediana + RI y porcentajes %.
Resultados: Ingresaron a UTI 190 pacientes con neumonía
con COVID-19. Requirieron ARM 155 (81 %) por más de 24 hs, de los cuales 56
(36%) fueron tratados con tocilizumab. La edad fue de 60±12 y el 68 % hombres.
El APACHE II 14±8 con riesgo de mortalidad del 53 %, el SOFA 4 ± 2 Los
pacientes que requirieron tocilizumab fueron más jóvenes (media, 60 frente a
64años; P = 0,05) y con menos probabilidad de tener enfermedad pulmonar crónica
(10 % frente a 28 %; p = 0,006) o enfermedad renal (35 % frente a 49 %; p =
0,08). Los pacientes tratados con tocilizumab tenían un dímero D más alto
(mediana, 4,4 frente a 2,5 mg/dL; P = 0,005). La PAFI de ingreso 112 [110-180],
decúbito prono 36 [64%]. Complicaciones: shock séptico 42 (70%), fallo renal 38
(60%), neumotórax 6 (10%). Los días de VM 12 [RI 8-15] y días de estadía en UTI
16 [9-20], la mortalidad global fue del 62 % y la mortalidad en pacientes con
tocilizumab fue de 48 % (p=menor a 0.05).
Conclusión: Nuestra población muestra predominio en
pacientes en edad media y sexo masculino, con scores de gravedad elevados. Se
asoció con una reducción de la mortalidad en pacientes tratados con
tocilizumab.
0351 Indicación de Biopsia
Estereotáxica en Diagnóstico de Hemorragia Intracerebral Espontánea.
M Villalobos, E
Quispe(1), Á Vélez(1), R Méndez(1), A Guarachi(1), M Altamirano(1), S Pérez(1),
M Mendoza(1), J Campos(1), J Condori(1), A Pedrazas(1), J Quispe(1), P
Villalobos(1)
(1) Sanatorio Del Oeste.
Introducción: Caso clínico de hematoma cerebral, ingresa
con tomografía normal y posterior hemorragia intracerebral y lesiones
secundarias. Con RMN se observan lesiones compatibles con secundarismo y
posible trombosis cerebral.
Caso clínico: Paciente de sexo femenino de 41 años, Ingresa
con cefalea holocraneana, disnea CF II, hiporreflexia tronco superior,
hipertonía de miembros inferiores, convulsiones, GCS 12/15, bradilalia,
desviación conjugada de la mirada. Antecedentes clínicos: Asma, 2 vacunas
Covid-19 / Covid Negativo, hipertensión arterial. Consumo de mate de ruda.
Tomografía de cerebro y tórax normal al ingreso, nueva convulsión en UCI, en
tomografía se observan 2 áreas espontáneamente hiperdensas (hematoma), edema
perilesional tipo digitiforme a nivel paraventricular derecho, occipital y
lóbulo occipital izquierdo localizadas a nivel subcortical. Fiebre 38 grados,
se realizan cultivos y punción lumbar. Diagnósticos: (Hematoma ICH Score I /
II), Intoxicación por Ruta graceolens, Trombosis venosa cerebral, Mielitis
transversa. LES, síndrome antifosfolipídico.
Se realizan estudios complementarios,
Centellograma captación de polos de ambos riñones. Serologías: Negativas Virus
hepátitis A, B,C, CMV, HIV. EBV. Alfafetoproteína, Ca 19-9, CEA, Ca- 125. Her: 1- 2. Negativas. RMN T1 ,
T2, GREE, Flair. Áreas de sangrado reciente que predominan en la región parietal,
parasagital subcortical derecha y en ambas regiones parietales. Con contraste
e.v, se observan múltiples imágenes de tinción nodulares de diferentes tamaños
la mayor de ellas en la región occipital y subcortical supratentorial derecha
que no mostraba sangrado, con edema perilesional impresionan Lesiones
Secundarias, con hemorragias intralesionales. La secuencia de difusión es
negativa, sin evidencia de isquemia reciente. Angioresonancia Normal.
Discusión: La obtención de muestras de tejido cerebral y
su posterior análisis es fundamental para la indicación terapéutica adecuada e
intervenciones quirúrgicas innecesarias. Es mínimamente invasivo, seguro y
eficaz.
Conclusión: La indicación Biopsia estereotáxica, en el
caso clínico que presentamos resulta fundamental por las variadas
manifestaciones clínicas que presentaba la paciente.
A Bordogna(1), G
Aparicio(1), P Castellani(1), C Lutkevicius(1), M Mendoza(1), M Rabino(1)
(1) Hiaep Sor María Ludovica.
Introducción: Los pacientes ingresados en la unidad de
cuidados intensivos (UCI) requieren intervenciones y dispositivos invasivos que
aumentan el riesgo de infecciones asociadas a los cuidados de la salud (IACS),
generando aumento de la morbimortalidad y de los costos en salud.
Durante la pandemia por SARS-CoV-2 se reportó
un aumento de IACS en las UCI de adultos, pero hay pocos datos sobre la
incidencia de las mismas en las UCI pediátricas.
Objetivo: Comparar la incidencia de IACS en una UCI
pediátrica antes y después del inicio de la pandemia por SARS-CoV-2.
Materiales y método: Estudio retrospectivo, descriptivo de las
IACS desde el 1/1/2018 al 31/12/2021 en una UCI pediátrica. Los datos se
obtuvieron de revisión de historias clínicas y base de datos SatiQ. Se
compararon los datos previos a la pandemia (2018-2019) y durante la pandemia
(2020-2021) utilizando chi cuadrado, considerando estadísticamente
significativo un valor de p<0.05.
Resultados: Total de ingresos: 1382, 758 en el primer
periodo y 624 en el segundo período.
Tabla 1- Características de la población

Tabla 2- IACS

Se observa una disminución estadísticamente
significativa del número de las IACS durante la pandemia, al igual que las ITU
asociadas a sonda. Si bien también hubo un descenso de los episodiso de BAC y
NAR, éstos no fueron estadísticamente significativos.
Conclusión: En nuestra unidad, a diferencia de lo
observado en las UCI de adultos, se observó un descenso de la incidencia global
de IACS durante la pandemia
Es difícil establecer la causa de estos
resultados ya que, al ser un estudio retrospectivo, algunas variables no
pudieron ser analizadas y también hubo menor porcentaje de ocupación durante la
pandemia.
Es probable que una adecuación en la relación
personal/paciente y las medidas de aislamiento necesarias para la atención del
paciente durante la pandemia, con el fin de reducir la exposición al
SARS-CoV-2, pudieron haber disminuido indirectamente la transmisión e infección
por otros gérmenes generando un efecto favorable en la prevención de IACS.
Estos resultados nos llevan a reforzar las
estrategias, como el uso de paquetes de medidas, la formación continua y la
información acerca del cumplimiento de las medidas propuestas, para obtener la
mejora de las medidas de prevención y mejorar la seguridad de los pacientes.
0353 DISFUNCIÓN PRIMARIA DE
INJERTO HEPÁTICO: REPORTE DE UN CASO
DG Sanchez(1)
(1) Hospital El Cruce.
Introducción: La disfunción primaria de injerto es uno de
los fenómenos de pérdida del injerto hepático que requieren inmediatamente
inclusión en lista de emergencia de trasplante. Presenta una incidencia del 0,9
al 7.2% de los trasplantes hepáticos.
Presenta rápido deterioro clínico del
paciente y requerimiento de retrasplante de emergencia.
Este deterioro severo agrava rápidamente el
estado de salud del paciente y produce severa morbimortalidad posterior al
retrasplante.
Presentación del caso: Paciente de 61 años con antecedentes de
cirrosis por alcohol, diabetes, que ingresa al servicio en el posoperatorio de
trasplante hepático, donante paciente masculino de 56 años, tiempo de isquemia
fría 9 horas 54 minutos. Presentó síndrome de reperfusión intraoperatorio
caracterizado por vasoplejía.
En las primeras 24 horas evoluciona Shock
hipovolémico con falla múltiple de órganos con requerimiento transfusional
masivo.
Se realiza doppler del injerto sin
alteraciones del flujo en vasos hepaticos. Con presencia de hematomas
subhepáticos.
Reingreso a quirófano en dos ocasiones para
lavado y colocación de packing por sangrado masivo, sin visualizar sitio de
sangrado activo.
Requirió dialisis por acidosis metabolica
refractaria y anuria.
Ingresa a lista de emergencia trasplante
hepático por disfunción primaria de injerto
Evolución: Se realiza trasplante hepático y
posteriormente evoluciona con mejoría lenta de las disfunciones, logrando ser
extubado a las 48 horas posoperatorio de retrasplante hepático.
Actualmente con buena función del injerto y
mejoría de disfunciones.
Discusión: En este caso el paciente evolucionó
posteriormente al trasplante con falla múltiple de órganos y coagulopatía
severa con sagrado evidente. Entre los dos diagnósticos diferenciales de la no
función del injerto, se realizó doppler del eje espleno-portal evidenciando
flujo en la arteria hepática, por lo que se interpreta como disfunción primaria
de injerto. Se coloca nuevamente en lista de trasplante de emergencia.
A la espera de un nuevo órgano, requirió
ingresar a quirófano en dos ocasiones, múltiples transfusiones y diálisis, con
progresión de sus fallas orgánicas.
Conclusiones: El trasplante hepático presenta múltiples
complicaciones, de las cuales la disfunción primaria del injerto es una de las
que presenta muy alta mortalidad. Requiere alta sospecha clínica e inclusión
rápida para retrasplante de emergencia. Es necesario un soporte vital avanzado,
multidisciplinario y coordinado, a la espera de un nuevo trasplante.

J Salvadores(1), F
Am(1), S Ramos(1), N Marquez(1), V Barrozo(1), M Singh(1), B Olocco(1)
(1) Sanatorio San Roque.
Introducción: Los enterococos son bacterias Gram positivas
que producen una gran variedad de infecciones comunitarias y nosocomiales. Se
ha documentado una progresiva resistencia de estas bacterias. La incidencia de
infecciones por Eneterococcus faecium resistente a vancomicina (ERV) ha
alcanzado proporciones alarmantes. Las opciones terapéuticas son muy limitadas.
La meningitis enterocócica es una infección muy infrecuente de la que se han
descrito 2 formas clínicas: postoperatoria, y espontánea, secundaria a
infecciones enterocócicas de otro origen.
Caso Clínico: Paciente femenino de 52 años con antecedentes
de Diabetes mellitus tipo II, Hipertensión Arterial, Tabaquismo, Sobrepeso,
Dislipemia con Diagnóstico de Hemorragia Subaracnoidea por malformación
arteriovenosa. Evoluciona con requerimiento de ARM, se realiza Craniectomía
suboccipital, clipeado aneurismático y excéresis de malformación arteriovenosa
de fosa posterior. Por Hidrocefalia se coloca Drenaje Ventricular Externo. Por
Neumonía asociada a la ventilación realiza tratamiento antibiótico con Vancomicina.
Intercurre con Síndrome Febril Prolongado, con deterioro neurológico
diagnóstico de Absceso Cerebeloso y fistula cutánea. Se realiza Punción Lumbar
con cultivo positivo para Eneterococo faecium resistente a Vancomicina. Se
realiza Drenaje quirúrgico del absceso. Se inicia Tratamiento con meropenem,
rifampicina y Linezolid por 28 días. Por adecuada evolución se coloca Drenaje
Ventrículo-Peritoneal. Actualmente con rehabilitación neurológica y Alta
Sanatorial.
Discusión: La meningitis por Enterococcus spp. Suele ser
de adquisición nosocomial en el 90% de los casos. Este caso ilustra la
capacidad de cepas de enterococo para generar resistencia a glucopéptidos. La
mayoría de los pacientes tienen una infección de origen nosocomial, secundaria
a procedimientos neuroquirúrgicos, como cirugía o derivación de liquido
cefalorraquideo (LCR), y han recibido previamente tratamiento antibiótico de
amplio espectro. La mayoría de los pacientes no responden a combinaciones de
múltiples fármacos intravenosos, ni al tratamiento intratecal.
Conclusiones: La meningitis por ERV suele presentarse como
una complicación nosocomial. El tratamiento de esta infección no ha sido
establecido, el linezolid puede ser considerado uno de los fármacos de elección
debido a su actividad frente a estos microorganismos y a su excelente
penetración en el LCR. Son esenciales el uso adecuado de antibióticos, la
educación del personal sanitario, la detección sistemática de EVR y el
cumplimiento riguroso de las medidas de control de infecciones.

J Pérez(1), JH
Dorado(1), E Navarro(2), DI Gilgado(1), GP Cardoso(1), I Telias(3), Department
Of Critical Care, St Michael’s Hospital, PO Rodriguez(6), M Accoce(1), L
Brochard(7), University Of Toronto, Toronto, Canada.
(1) Sanatorio Anchorena San Martin. (2)
Centro Del Parque. (3) Keenan Research Centre And Li Ka Shing Institute. (4) Department Of Critical Care. (5) St Michael’s Hospital. (6) Cemic. (7)
Interdepartmental Division Of Critical Care Medicine. (8)
University Of Toronto. (9)
Toronto. (10) Canada.
Introducción: La transición a presión soporte (PSV) tras
pruebas de despertar espontáneo (PDE) ha demostrado ser compleja en sujetos con
ventilación mecánica invasiva (VMi) por COVID-19. La intolerancia a PSV no ha
sido descripta como evento, tampoco sus predictores y resultados clínicos
asociados.
Objetivo: Describir la incidencia del fallo en tolerar
PSV en COVID-19 bajo VMi, predictores e impacto clinico. Secundariamente,
comparar la incidencia de fallo con una cohorte de pacientes con insuficiencia
respiratoria (IR) hipoxémica de otras etiologias.
Método: Se incluyeron sujetos con COVID-19, VMi
>12hs y PaO2/FiO2Las comparaciones grupales se realizaron mediante test
Wilcoxon-Mann-Whitney o test exacto de Fisher, según corresponda. Para
determinar predictores y asociación de COVID-19 con el fallo se utilizó un
modelo de regresión múltiple lineal generalizado construido mediante stepwise
backward regression. La bondad de ajuste se evaluó con test Hosmer-Lemeshow.
Una p
Resultados: Entre abril-2019 y agosto-2022 se incluyeron
189 sujetos con COVID-19. Un 95.0% cumplió criterios de síndrome de distrés
respiratorio agudo (SDRA). La incidencia de fallo fue 49.7%. El APACHE II al
ingreso, el índice de masa corporal (IMC), el bloqueo neuromuscular previo y la
PaO2/FiO2 y el pH inmediatamente previos a la PDE fueron predictores
independientes del fallo (Tabla 1). Quienes fallaron tuvieron menos
extubaciones, más reintubaciones, traqueostomía, días de VMi, estadía y
mortalidad (Tabla 2). Al comparar con 85 sujetos con IR de otras etiologías
(77% SDRA), el fallo de PSV fue mayor en COVID-19 (29.4% versus 49.7%;
p=0.002). Tras ajustar por confundidores, el diagnostico COVID-19 incrementó
independientemente las chances de fallo (OR 2.10 [1.10–4.09, 95%IC]; p=0.028).
Conclusión: La incidencia de fallo de PSV fue 49.7%. El
APACHE II, IMC, bloqueo neuromuscular, PaO2/FiO2 y pH se asociaron con el
fallo. Quienes fallaron tuvieron peores resultados clínicos. El fallo de PSV en
COVID-19 fue mayor comparado con IR de otras etiologías.


0356 Evaluación del flujo
uterino en gestante con shock cardiogénico bajo soporte ECMO
ML Ojeda(1), L
Perez(1), L Haddad(1), M Acebo(1), F Molina(1), D Otalora(1), C Ballesteros(1),
L Aguirre(1), F Klein(1)
(1) Fundacion Favaloro.
Introducción: El soporte de ECMO en gestantes ha sido
indicado en distrés respiratorio, shock cardiogénico y paro cardíaco
observándose tasas de supervivencia superiores al 70% para la madres y el feto.
Se desconoce a la actualidad si el ECMO V-A altera la pulsatilidad del flujo
uterino.
Presentación del caso: Femenino de 19 años, trasplantada cardiaca en
03/2020 por miocardiopatía dilatada idiopática, inmunosuprimida con deltisona y
tacrolimus, cursando embarazo de 14 semanas, ingresó a nuestra institución en
contexto de shock cardiogénico de 24 hs de evolución con requerimiento de
Milrinone, Dobutamina, Noradrenalina y Levosimendán, por sospecha de rechazo
del injerto evolucionando con shock refractario con requerimiento de ECMO V-A
femoro-femoral, como puente a la recuperación o retrasplante. La evolución
clínica se describe en la Tabla 1. Se evaluó viabilidad fetal con ecografías
obstétricas y valoración doppler del flujo sanguíneo en las arterias uterinas
utilizándose el índice de pulsatilidad (IP). (Ver Figura 1). Evolucionó con
pérdida de gestación (hemorragia por rotura femoral) y resolución de shock
otorgándose egreso el día 70.
Discusión: Las arterias uterinas son estructuras
cambiantes durante la gestación. Al inicio del embarazo presentan patrón de
bajo flujo y alta resistencia, con posteriores cambios que generan una pérdida
de la capa muscular vascular, convirtiéndolas en vasos capaces de manejar
grandes volúmenes sanguíneos y con bajas resistencias. La valoracion del flujo
Doppler y las características de la placenta han logrado encontrar una relación
directa entre la histopatología de las arterias uterinas y la perfusión
placentaria, utilizándose en la evaluación de la placentación normal y la
detección de complicaciones obstétricas, como la Preeclampsia/Eclampsia y el
RCIT, cuyo origen está en una placentación inadecuada o anómala. En este
reporte de caso utilizamos esta evaluación para determinar si el flujo continua
y los altos volúmenes circulatorios en ECMO podrían alterar la viabilidad fetal,
sin evidenciar alteraciones.
Conclusión: El ECMO es un soporte disponible para
pacientes gestantes con Insuficiencia respiratoria y Shock, sin alterar la
viabilidad fetal, permitiendo ser utilizado en pacientes seleccionados.


M Acebo Acha(1)
(1) Fundación Favaloro.
Introducción: La enfermedad Veno-oclusiva es una
complicación potencialmente mortal que se desarrolla en hasta el 15% de los
adultos que se someten a un trasplante de células hematopoyéticas. La
insuficiencia hepática aguda (IHA) asociada es poco frecuente y de difícil
manejo.
Presentación del Caso: Femenina de 25 años con antecedente de
Leucemia Linfoblástica Aguda (LLA) que recibió esquema de GATLA-AYA. El
06/06/2022 se realizó Trasplante Medula Ósea (TxMO) Alogénico Haploidéntico sin
complicaciones con egreso institucional al día 20 post-trasplante. Reingresó el
01/07/2022 por dolor abdominal y fiebre evolucionando con IHA. Se realizó
Angiotac de abdomen evidenciando trombosis portal no oclusiva con hígado
heterogéneo en tiempo venoso. Evolucionó con encefalopatía el día 08/7/22,
realizándose monitoreo neurointensivo con eco doppler transcraneano
evidenciando hiperemia, y valoracion de la vaina del nervio óptico: 4.8mm. Por
IHA se ingresó a lista de emergencia para Transplante Hepático (TxH),
trasplantándose el 09/07/2022. El estudio anatomopatológico del órgano explantado
confirmo el diagnostico de enfermedad venocolusiva hepática (EVOH). Como
complicaciones post TxH presento: Microangiopatía trombótica (ADAMTS13+),
retardo en el despertar por actividad epileptiforme no convulsiva, reactivación
de CMV, infección por rinovirus, COVID 19 leve, cistitis hemorrágica por virus
BK, y neumonía por stenotrophomonas maltophilia. Evoluciono sin nuevas
intercurrencias a la fecha.
Discusión: La EVOH se caracteriza por daño endotelial en
los sinusoides hepáticos que se amplifica por una respuesta inflamatoria local
y la activación de las vías de coagulación y fibrinolíticas, relacionada con
los agentes alquilantes en regímenes de acondicionamiento, radiación ionizante
o hepatotoxinas, y en casos graves postTxMO muestran una sobrevida del 2 al
10%. Reportamos una serie de 19 casos (incluido el nuestro) de la literatura
tratados con trasplante hepático con una sobrevida del 35% (Ver Tabla1).
Conclusión: A pesar de la alta mortalidad relacionada con
la inmunosupresión (infecciones). La serie de caso reportada en este trabajo,
muestra una mejoría en la sobrevida en los pacientes con EVOH grave luego del
TxH comparado a los reportes previos, haciendo al TxH una opción terapéutica
razonable en estos pacientes.


PG Insaurralde(1), J
Leiria(1), I Garcia(1), M Abbate(1), V Thomas(1), N Etchechoury(1), F
Gonzales(1)
(1) Hospital Zonal Trelew.
Objetivo: Evaluar la titulación de PeeP y su impacto en
la Presión Meseta en pacientes Obesos Mórbidos con SDRA COVID 19.
Material y Método: Estudio prospectivo observacional en el
periodo comprendido entre 01/07/2020 al 01/06/2022 en el que ingresaron 26 pacientes
Obesos Mórbidos IMC( 52 +- 5 )con SDRA COVID 19. Recibieron ventilación
mecánica protectora Vt 4-6 ml/kg. Y titulación de peep a través de la mejor
compliance (cest)respetando presiones meseta por debajo de 30 cmho2 y presión
de distensión por debajo de 15.
De los 26 pacientes, 8 pacientes no
obtuvieron mejoría inicial en la oxigenación Pafi ni en la cest. Se decide
realizar maniobra de reclutamiento alveolar 45 – 40. y retitulacion de peep a
través de la mejor cest. tolerando presiones meseta mayores de 30 cmho2.
Resultados: Del análisis comparativo antes y después de
realizar maniobra de reclutamiento alveolar y retitulacion de peep a través de
la mejor cest. Se observa un incremento promedio de la pafi de 103 +- 16 ,
incremento de la cest de 18 +- 3) aumento de la presión meseta de 4 +- 2 cmho2
mas incremento promedio de la peep de 5 cmho2 +-3, manteniendo una presión de
distensión de 13 +-4.
Conclusión: En la muestra estudiada ,optamos por tolerar
presiones mesetas por encima de 30 cmho2 asumiendo el impacto de la baja
elastancia del tórax en este grupo de pacientes.
LY Haddad(1), L
Perez(1), F Molina(1), M Acebo(1), L Ojeda(1), D Otálora(1), C Ballesteros(1),
G Pantoja(1), L Aguirre(1), F Klein(1)
(1) Fundación Favaloro.
Introducción: La sífilis es una enfermedad infecciosa
producida por el Treponema pallidum, generalmente de transmisión sexual y puede
manifestarse clínicamente como sífilis primaria, secundaria, terciaria o
latente. La incidencia ha tenido un marcado aumento en los últimos años tanto
en argentina como en el resto del mundo.
Presentación del caso: Femenina de 20 años de edad, sin antecedentes
patológicos, oriunda de la ciudad de Jujuy, ingresó derivada por IHA para
evaluación de trasplante hepático (TXH) en calidad de emergencia. Relató cuadro
clínico de 8 días de evolución caracterizado por ictericia progresiva, coluria,
intolerancia digestiva con posterior aparición al día 6 de lesiones maculares
rojo-violáceas en cara, cuello, y MMSS, sin adenomegalias (ver Figura 1). De
los exámenes realizados al ingreso se destacó pruebas de función hepática
anormales (Tabla 1) y pruebas no treponémicas y treponémicas reactivas por lo
que se inició tratamiento antibiótico con Penicilina endovenosa. Evoluciono a
las 12 hs del ingreso con encefalopatía (somnolencia, bradipsiquia, flapping)
realizándose monitoreo de vaina del nervio óptico: 4.7mm, y eco doppler
transcraneano con índice de pulsatilidad de 1.1, ingresando en lista de
emergencia TxH, trasplantándose en las siguientes 24 horas. Como complicaciones
post trasplante presentó sangrado de vena suprahepática y arteria hepática
requiriendo reintervención quirúrgica, y tratamiento antibiótico por
colonización del líquido trasplante con EVR, con posterior evolución favorable,
egresando el día 10.
Discusión: La hepatitis sifilítica es una entidad poco
frecuente, descripta en aproximadamente 0,2% de los casos siendo más frecuente
su presentación en pacientes con coinfección por HIV. El compromiso hepático
puede darse en cualquier etapa de la sífilis con la diseminación hematógena
como principal hipótesis de migración del Treponema luego de demostrarse la
presencia de esta espiroqueta en biopsias hepáticas. Existen solo algunos
reportes de casos de TxH para el manejo de esta entidad.
Conclusión: La prevención y tratamiento oportuno de la
sífilis son el Gold Estándar para su manejo, pero en los casos de IHA el
trasplante Hepático en una opción en casos selectos.


0362 MOTIVOS DE INGRESO
OBSTETRICOS EN TERAPIA INTENSIVA
MM Barraza(1), GA
Levy(1), RA Karatanasopuloz(1), AR Serruya(1), LV Gossen(1), MF Mendieta(1), JC
Flores(1), SA Gimenez Pedemonte(1), M Barrios D´ambra(1)
(1) Hospital J. R. Vidal.
Introducción: Los motivos de ingreso obstétricos a la
Unidad de Terapia Intensiva (UTI) son de gran relevancia para la comprensión
objetiva de la morbi-mortalidad materna además de las implicancias que se
generan por tratarse de pacientes jóvenes cursando embarazo o puerperio.
Objetivos: Determinar los motivos de ingresos a UTI de
pacientes obstétricas tanto causas relacionadas a la gestación como otras
causas.
Materiales y métodos: Estudio retrospectivo de tipo trasversal que
incluye ingreso de pacientes embarazadas o puérperas a la UTI del Hospital J R
Vidal de la ciudad de Corrientes durante el periodo julio 2021 a julio 2022.
Resultados: Durante el periodo de un año del estudio
ingresaron 21 pacientes obstétricas a UTI es decir 1 ingreso cada 133 partos o
cesáreas. La edad promedio fue de 27 años, siete ingresaron durante embarazo
(33%) y catorce lo hicieron en el puerperio (66%). En relación a las causas de
internación, 6 correspondían a patologías no relacionadas al embarazo (25%) y
el resto a patologías relacionadas a la gestación (75%). Motivos de ingreso:
eventos hemorrágicos 4 (22%), trastornos hipertensivos 7 (33%), sepsis 6 (22%)
miocardiopatía periparto 2 (9%) y otros 2 (9%). Registramos 2 muertes maternas,
una por hipernatremia extrema por diabetes insípida y la otra por diabetes
miellitus pregestacional con insuficiencia renal aguda y sepsis grave por
catéter.
Conclusión: Los trastornos hipertensivos los eventos
hemorrágicos y la sepsis fueron las principales causas de ingreso a UTI en
pacientes obstétricas, y 25 % ingresaron por patologías no relacionada al
embarazo.

DA Otálora
Lozano(1), LC Pérez(1), MA Acebo Acha(1), LY Haddad(1), FA Molina Jiménez(1), L
Ojeda(1), RA Noreña(1), S Finoli(1), L Aguirre(1), F Klein(1)
(1) Fundación Favaloro Hospital
Universitario.
Introducción: La Histiocitosis de células de Langerhans
(HCL) es una rara enfermedad que afecta aproximadamente de 1.4 a 4 por cada
millón de nacimientos por año, considerada como una forma de cáncer que abarca
un amplio espectro de manifestaciones inflamatorias. La variante multisistémica
(HCL-MS) con compromiso pulmonar es prevalente en niños entre 6 meses y 12 años
de edad con mayor pico diagnóstico entre 3 y 4 años, muy pocos de los cuales
han requerido de trasplante bipulmonar.
Presentación del caso: Masculino de 19 años con antecedente de
enfisema bulloso diagnosticado en 2020 no tabaquista, dermatosis en cuero
cabelludo, derivado de la Ciudad de Rosario por neumonía bacteriana grave que
progresó a falla ventilatoria y luego hipoxemia refractaria requiriendo
asistencia con oxigenación por membrana extracorpórea (ECMO) (Ver figura 1).
Posteriormente fue trasladado a nuestra terapia intensiva para trasplante bipulmonar
de emergencia. Como complicaciones presentó sepsis a foco pulmonar, diabetes
insípida central, y sangrados relacionados con la anticoagulación y la
asistencia. Se tomaron muestras respiratorias por lavado bronquioalveolar con
hallazgos inespecíficos en anatomía patológica y biopsias de cuero cabelludo
que informaron hallazgos microscópicos e inmunohistoquímicos sugestivos para
HCL (Ver figura 2). Estuvo 66 días asistido, sin embargo evolucionó con
progresión de fallas multiorgánicas y finalmente falleció.
Discusión: La HCL-MS en el grupo etarío del paciente es
casi insospechada, más aún presentándose como enfisema bulloso. Este reporte de
caso describe la importancia del diagnóstico bajo soporte de ECMO como puente a
la decision, ya que en el momento de la asistencia no se contaba con
diagnóstico etiológico.
Conclusión: El diagnostico etiológico permite pronóstico
en la evolución de la patologia de base y post trasplante en los pacientes con
insuficiencia respiratoria. Los reportes de casos de trasplante bipulmonar en
pacientes con HCL-MS han informado altas tasas de fracasos en quienes no
recibieron tratamiento específico para esa enfermedad. El ECMO como puente a la
decisión permitió en este caso la estabilizacion del paciente, para llegar a un
diagnóstico etiológico definitivo.


0364 TAKOTSUBO ASOCIADO A
SINDROME DE DISTRES RESPIRATORIO AGUDO POR COVID-19
M Singh(1), F Am(1),
J Moreno(1), R Sanitllan(1), S Gerez(1), L Panozo(1), A Jove(1), N Orosco(1), F
Enriquez(1), M Dell Aqcua(1), S Ramos(1), J Salvadores(1)
(1) Sanatorio San Roque.
Introducción: La miocardiopatía de takotsubo es una
enfermedad autolimitada que puede estar asociado a infección por SARScov-2.
Cuando la afectación es biventricular, se asocia con malos resultados tanto en
el hospital como a largo plazo. Durante el Sindrome por Takotsubo, se produce
una alteración de la modulación del receptor beta-adrenérgico con posible
depresión transitoria de la contracción miocárdica. El creciente número de
casos se ha atribuido a la infección asi como a los múltiples factores
estresantes relacionados con la pandemia. En un estudio de Chang et al, la
infección por COVID-19 estuvo presente en el 66,7 % de los pacientes, con
takotsubo.
Caso Clínico: Paciente femenino de 53 años con antecedentes
de Hipertensión Arterial, Tabaquismo, no vacunada para COVID-19 ingresa
cursando Neumonía bilateral por covid- 19. Al 7mo día evoluciona con
requerimiento de Cánula Nasal de Alto Flujo, sin respuesta con diagnóstico de
Sindrome de Distres Respiratorio se decide intubación orotraqueal. Se realiza
Ecocardiograma con Facción de eyección (Fey) de 65%. Intercurre con
requerimiento de vasopresores por Shock séptico inicia tratamiento antibiótico.
Por vasoplejia persistente se decide realizar Ecocardiograma de control con
Diagnostico de Takotsubo Fey de 25%. Inicia tratamiento con inotrópicos,
diuréticos, betabloqueantes. Evoluciona con adecuada respuesta.
Ecococardiograma con Fey conservada 55% iniciando proceso de destete con
mejoría clínica posterior alta hospitalaria.
Discusión: El Síndrome de Distres respiratorio agudo
severo por SARS-CoV-2 es afección que afecta en mayor medida a población
adulta, con una mayor mortalidad en pacientes con comorbilidades y en pacientes
no vacunados. La identificación de lesión cardíaca aguda y arritmia se
encuentra asociado a la afección sistémica del virus. En el caso presentado el
deterioro de la función cardiaca se encuentra claramente comprometida por el
Síndrome de Takotsubo en contexto de Neumonía Grave bilateral
Conclusiones: En la era del COVID-19, debemos prestar
atención a una variedad de condiciones cardiovasculares. El síndrome de
Takotsubo es una de estas condiciones que pueden desencadenarse por la inflamación
sistémica asociada a infección viral. Aunque los tratamientos específicos para
mejorar el pronóstico aún son inciertos, los datos sugieren un impacto
favorable de los inhibidores de la enzima convertidora de angiotensina o los
bloqueadores de los receptores de angiotensina.


C Sotelo(1), A
Vides(1), M Corona(1), J Maidana(1)
(1) San Bernardo.
Introducción: Las infecciones necrotizantes de piel y
partes blandas son un grupo heterogéneo de entidades que provocan en el 30% de
los pacientes shock, fallo multiorgánico y muerte. Se desconoce la prevalencia
de SAMR de la Comunidad (CA-MRSA) en Argentina, de acuerdo a las últimas
publicaciones se vio en aumento su presentación nuestro medio
Caso clínico: Paciente Femenina de 37 años sin antecedentes
patológicos. Ingresa por dolor e impotencia funcional de miembro inferior
(MMII) izquierdo con signos de flogosis. Al examen físico: lúcida, hipotensa,
taquicardia, afebril, edema unilateral godet (+) hasta pliegue inguinal, pulsos
periféricos conservados. Al ingreso, SOFA: 5, Score LRINEC: 10. Eco Doppler:
TVP negativo. Se toman cultivos, se inicia ATB. A las 24 hs, complica con
shock, al laboratorio: GB: 10400, TP: 43%, RIN: 1.86, KPTT: 47 seg, Plaquetas:
137000, Sodio: 123, GOT: 322, Bilirrubina Total: 4.4, pH: 7.04, pCO2: 30, pO2:
47, HCO3: 7.8, EB: -20.7, Lactato: 8.2, CPK: 12541, Procalcitonina: 4.73, APACHE
II: 22, SOFA: 10. Tomografía sin colecciones ni burbujas. A las 48 hs, presenta
alteración del sensorio en menos, dosis crecientes de vasoactivos y ARM. Se
realiza toilette quirúrgica por Celulitis Necrotizante (TCS de aspecto
gangrenoso, fascia conservada). Se inicia Hemodiálisis en agudo. 6 hs después
de dicha intervención quirúrgica presenta PCR y obito.
Informe póstumos de cultivo Bacteriológico de
TCS y hemocultivo x2, ambos positivos para Staphylococcus Aureus M. Resitente
Discusión: Las infecciones necrotizantes por CA-MRSA son
de diagnóstico dificultoso y consulta tardía. Se suelen presentar con dolor,
afebriles y sin compromiso del estado general, el plazo hasta identificar el
curso fulminante es variable, si el índice de sospecha de lesión necrotizante
es elevado la evaluación quirúrgica es urgente.
Conclusión: Aún con inicio de tratamiento antibiótico de
amplio espectro y conducta quirúrgica temprana, la mortalidad de las
infecciones necrosantes por CA-MRSA es elevada, constituyendo una urgencia
infectológica, la complejidad del cuadro amerita atención multidisciplinaria en
UCI, como es el caso de esta paciente cuyo óbito ocurre a los 4 días.


0367 DIABETES INSIPIDA EN EL
EMBARAZO
AK Marquez(1), E
Hualpa Yucra(2), Moron, J Claros Ibañez(4), Moron, D Mariano Da Silva(2),
Moron, N Navarro(2), Moron, A Salguero(2), Moron, G Miglioretti(2), Moron, PG
Gil(2), Moron, S Kulling(2), Moron, V Peregrina(2), Moron, N Varrenti(2),
Moron, AK Marquez(2), Moron, F Campero(2), Moron, A Alarcon(2), Moron, G
Moreno(2), Moron
(1) Ostaciana B. Lavignole. Moron. (2)
Ostaciana B. Lavignole. (3) Moron. (4)
Ostaciana. B Lavignole. (5) Moron.
Introducción: La diabetes insípida gestacional es un
trastorno poco común, su incidencia es 1/ 30.000 gestaciones.
persona gestante de 25 años embarazada de 34
semanas presento eclampsia evoluciona con, poliuria es importante el
diagnóstico y tratamiento oportunos.
Presentacion del caso: Persona gestante, consulta por convulsiones e
hipertension arterial, interpretandose eclampsia requirió cesárea de urgencia,
AVM. se indico antihipertensivos y sulfato de magnesio. Evoluciona con poliuria
de 166 ml/h a 600 ml/h, proteinuria, hipostenuria (densidad urinaria <
1.005). Interpretando diabetes insípida se inicia desmopresina 2 mcg cada 24 hs
disminuyendo la diuresis 300-400 ml/h, posteriormente desmopresina intranasal
40 mcg/día con respuesta diuresis de 100 ml/hora. Se restablecio la osmolaridad
urinaria, evoluciona normotensa, y con mejoría de su estado neurológico
logrando el weaning y extubación. La Resonancia Magnética Nuclear evidenció
tumor en silla turca.
Discusión: La diabetes insípida (DI) se caracteriza por
una secreción, degradación o actividad anormal de la vasopresina. Se distinguen
dos tipos central y nefrogénica, incorporándose el tercer tipo, gestacional o
transitoria del embarazo.
La Diabetes insipida gestacional es rara
complicación del embarazo, incidencia entre 4 a 6 casos por cada 100000
embarazos, la mayoría de las veces transitoria. Se ha relacionado a otras
entidades como preeclampsia, eclampsia, hígado graso , síndrome HELLP y de
Sheehan. El presente caso se asoció a un cuadro de eclampsia. El diagnóstico
puede comprender tres grandes grupos: 1)Formas subclínicas. 2) Por patología
hipotálamo-hipofisaria desconocida hasta ese momento.3) Formas asociadas a
patologías hepáticas gestacionales.
Se debe sospechar al instalarse el síndrome
poliúrico-polidipsico, cabe recordar que durante el embarazo la osmolaridad
sérica disminuye aproximadamente 10 mOsm/ kg en forma fisiológica, así como que
una densidad urinaria menor de 1.005, asociada al síndrome
poliúrico-polidipsico, es sumamente orientativo para el diagnóstico
diferencial.
Conclusiones: En este caso el diagnóstico es una diabetes
insípida central por un tumor de la silla turca, no debemos dejar de pensar
como diagnósticos diferenciales, ya que la diabetes insípida en el embarazo es
una entidad poco frecuente que puede desencadenar un estado de deshidratación severa
con hipernatremia y su consecuente afectación neurológica. La importancia del
diagnóstico precoz para evitar las complicaciones tanto a nivel materno como
fetal.

AJ Alarcon
Marinoni(1), C Farqhuarson(1), S Ribak(1), AE Carrera, M Pohlemann(1), M
Argüello(1), D Acosta(1), M Kaechele(1), N Barreto(1), R Otrowski(1), V
Romina(1)
(1) Hospital Escuela De Agudos Ramon
Madariaga.
Introducción: La hepatotoxicidad por drogas y sustancias,
denominada mundialmente como drug induced liver injury (DILI), es una entidad
cuya incidencia es desconocida debido a la escasez de estudios prospectivos
poblacionales, pero se debe considerar siempre la posibilidad de DILI en
pacientes con enfermedad hepática aguda idiopática. La cocaína tiene efectos
nocivos en su consumo y sobredosis, por su potente efecto vasoconstrictor
secundario a liberación de hormonas catecolaminérgicas como por su inhibición
de la recaptación de noradrenalina. Describimos un caso con falla hepática
aguda fulminante y disfunción multiorgánica.
Presentación del caso: Paciente de 28 años, consumidor habitual de
sustancias psicotrópicas (consumo de cocaína más alcohol) con falla renal,
insuficiencia hepática, coagulopatía severa e hipoglucemia; serologías para
enfermedades virales (HCV/HBV/HCV/HIV) negativas. Falla hepática severa
secundaria a DILI (por cocaína + alcohol)
Discusión: Los fármacos asociados con DILI (mecanismo de
hepatotoxicidad) pueden causar lesiones de una manera predecible y dependiente
de la dosis, o de manera impredecible (idiosincrásica). Se han realizado múltiples
estudios, en roedores, demostrando la capacidad hepatotóxica dosis y tiempo
dependiente de la cocaína a través de mecanismos relacionados con el sistema
P450. La peroxidación lipídica y la formación de radicales libres serían la
causa de la hepatotoxicidad por cocaína, la escasez relativa de casos de
hepatotoxicidad grave por cocaína sugiere algún modo de susceptibilidad o la
asociación de cofactores en los casos graves. Es frecuente, que al daño
hepático por cocaína se asocia rabdomiolisis. El potente efecto vasoconstrictor
que genera provocaría una disminución del flujo sanguíneo hepático y una
isquemia mantenida sobre el músculo esquelético responsable de la
rabdomiolisis. El descenso del índice de Quick y los datos de encefalopatía
hepática permitan clasificarlo como fallo hepático fulminante de acuerdo con
los criterios de O’Grady
Conclusión: Se presenta, un caso de insuficiencia
hepática aguda fulminante asociada al consumo de cocaína, asociado a fallo
multiorgánico. Dada la prevalencia de su consumo, pensamos que debe tenerse en
cuenta la cocaína como posible agente etiológico en casos similares de
hepatitis aguda grave.
AM Antón(1), R Giannoni(1),
MG Arce(1), IS Gonzalez Pompilio(1), V Jozami, FF Giannoni, RO Marañon(2)
(1) Regional Ramón Carrillo. (2) Conicet.
Los trastornos hipertensivos del embarazo
(THE) son considerados la principal causa de morbimortalidad materna y de
ingreso a cuidados críticos de causa obstétrica. La insuficiencia renal aguda
(IRA) se asocia con mala evolución materno fetal, sin embargo, no existe
suficiente evidencia sobre la incidencia de la IRA en los THE.
Objetivos: Determinar la incidencia de la injuria renal
aguda en los trastornos hipertensivos del embarazo y su incidencia durante la
internación y admisión.
Métodos: Estudio de cohorte retrospectivo. Se
enrolaron pacientes que ingresaron desde 01/11/2017 al 01/07/2022 a Terapia
Intensiva con diagnóstico de THE. Criterios de inclusión: THE: preeclampsia
severa, síndrome HELLP, eclampsia, preeclampsia sobreimpuesta (según ACGO), internadas
en terapia intensiva por 48hs. Se excluyeron mujeres con disfunción renal
subyacente e insuficiencia renal crónica. Durante la admisión se midieron datos
antropométricos y epidemiológicos, comorbilidades, necesidad de vasopresores,
ventilación mecánica y uso de diuréticos, escores de SAPS II y APACHE II, datos
hemodinámicos y laboratorio de admisión. Durante la internación se registraron
balances de fluidos acumulados hasta 48hs del ingreso. Se registró el tiempo de
internación en terapia intensiva y hospitalaria y la mortalidad hospitalaria.
Resultados: Ingresaron a UTI, 179 pacientes con THE graves. El 70% presentó IRA
a la admisión, 58% pacientes admitidos y 42% dentro de las 48hs. Estas
presentaron más muerte fetal, uso de vasopresores y ventilación mecánica a su
admisión. Adicionalmente, fueron más graves al ingreso (SAPS II y APACHE II).
Las pacientes con IRA presentaron mayor diálisis durante su internación y
mortalidad. El ácido úrico fue mayor en las pacientes con IRA a la admisión.
Los niveles de presión arterial media a las 48hs fueron más bajos en pacientes
con IRA durante la internación.
Conclusión: La insuficiencia renal aguda es frecuente en
los trastornos hipertensivos del embarazo. El desarrollo de IRA durante la
internación se asoció con malos resultados materno fetales.

0370 SOPORTE EXTRACORPOREO EN
TANDEM: REPORTE DE CASO
E Manrique(1), J
Bernasconi(1), Y Lombi(1), R Avila(2)
(1) Hospital Privado Universitario De
Cordoba. (2) Hospital Universitario De Cordoba.
Introducción: El soporte extracorpóreo en ocasiones
requiere dos modalidades, por ejemplo, plasmaféresis y terapia de reemplazo
renal continua (TRRC). Presentamos el caso de una paciente con fallo hepático
agudo fulminante por hígado graso agudo del embarazo.
Presentación del caso: Femenina de 31 años, primigesta, de 29
semanas de gestación es derivada por insuficiencia hepática aguda. Se
interrumpió el embarazo. Evolucionó con encefalopatía grado IV, fallo renal
agudo AKI III, inestabilidad hemodinámica e hipertensión endocraneana. Se
indicó soporte extracorpóreo con HDFVVC y PAV en tándem.
Se colocó un catéter de doble luz de 13,5 Fr/
23 cm de largo, en la vena femoral derecha. Se utilizaron máquinas Amplya
(Bellco / MedTronic). Se conectaron dos dispositivos de doble luz en “Y”a las
extremidades arteriales y venosas del catéter (Figura 1).
En ambos soportes se programó un flujo
sanguíneo de 150 ml/h. En el caso de la PAV, se realizó un recambio plasmático
del 15% del peso corporal ideal (8-12 L) con plasma fresco congelado. En el
caso de TRRC se utilizó una dosis de 35 ml/kg/h, sin anticoagulación. No hubo
cambios en las lecturas del monitor de las presiones venosas, arteriales ni
transmembrana. El estado hemodinámico y neurológico de la paciente mejoró, con
reducción de noradrenalina a más del 50% de la dosis inicial y mejor control de
la presión intracraneana. Se objetivo una disminución en la analitica de ácidos
biliares, bilirrubina total y directa, interleucina IL-6 (Tabla 1). A las 48 h
se realizó el TH sin complicaciones.
Discusión: La utilización de dos soportes extracorpóreos
simultáneamente permite acortar el tiempo de tratamiento y el uso de un único
acceso, con menor riesgo de complicaciones, sin alteraciones en la hemodinamia
de los circuitos, permitiendo realizar ambas modalidades cumpliendo sus
objetivos. En este caso se pudo realizar un adecuado manejo sin demoras ni
complicaciones hasta el trasplante hepático.
Conclusión: La terapia de soporte extracorpóreo en tándem
PAV/TRRC puede permitir un adecuado manejo de pacientes que requieran doble
soporte sin alterar la calidad del procedimiento y minimizando las
complicaciones.


0372 INTOXICACIÓN CRÓNICA DE
PLOMO POR HERIDA DE ARMA DE FUEGO
BF Acosta Torres(1),
JP Klein(2), F Condori(2)
(1) H. Nac: Alejandro Posadas. (2) H. Nac
Alejandro Posadas.
Introducción: La intoxicación por metales pesados pueden
causar daño a órganos, cambios de comportamiento y trastorno de la conducta.
Los síntomas de intoxicación por metales pesados, en este caso plomo, dependen
de cuanto hay en su cuerpo, edad del paciente y el tiempo en contacto con dicho
metal.
Presentación: Se presenta el caso clínico de un paciente
masculino de 31 años, albañil, procedente de San Carlos de Bariloche -
Argentina. Quien consultó al Hospital zonal de Bariloche, por cuadro clínico de
72 hrs de evolución caracterizado por dolor abdominal en región periumbilical y
epigastrio que no calma con AINES. Se descarta mediante correlacion
clinico-radiologica toda causa medico/quirurgica del cuadro abdominal y
teniendo el antecedente de herida de arma de fuego hace 8 años en articulación
glenohumeral izquierdo, se llega al diagnóstico presuntivo de probable
intoxicación crónica por plomo.
Discusión: La intoxicación por plomo secundaria a
proyectiles alojados en el cuerpo humano es una entidad poco diagnosticada,
pero puede ser mortal si no se reconoce. Estos proyectiles alojados en las
articulaciones son más propensos a desarrollar esta complicación debido al
contacto con líquido sinovial. Hallazgos sutiles como la aparición de anemia de
causa inexplicable, cólicos abdominales o deterioro neurológico en pacientes
con historia de herida por proyectil puede sugerir el diagnóstico de
saturnismo.
Conclusión: Conocido el potencial de la intoxicación
plúmbica y repercusión sistémica relacionada al tiempo de dicha exposición como
a las concentraciones sanguíneas de dicho metal, es necesario el manejo
multidisciplinario que incluye de inicio el uso de quelantes con el fin de
evitar redistribución del metal y posteriormente el retiro del mismo mediante
cirugía.


0374 Retiro de Soporte vital.
Extubaciòn terminal en paciente crìtico
M Bezzati(1), A
Martinez(1)
(1) Italiano De Buenos Aires.
Introducción: El gran desarrollo de la Medicina Intensiva
de los últimos años ha modificado de manera significativa el pronóstico de
muchas enfermedades que previamente conducían de manera inexorable y rápida a
la muerte.
Se debe comprender que la prolongación del
soporte vital puede retrasar el momento de la muerte, pudiéndose enmarcar en la
figura de ensañamiento terapéutico .
Presentación del caso: Paciente de 78 años cursò 49 días de
internaciòn en unidad de terapia intensiva con diagnóstico de lesiòn medular
incompleta secundaria a politraumatismo por caída de altura.
Examen neurológico que evidencia paraplejia
,reflejo babinsky positivo y nivel sensitivo en T1-T2.
PANTomografia: colección subdural frontal.
Hemorragia Subaracnoidea frontal izquierda
Hematoma epidural cervical alto.
Fractura costal 8° 9° 10°.
Se interpreta como síndrome medular con
déficit motor progresivo
Se realiza artrodesis cervical por vía
anterior.
- Aspecto neurológico : Escala ASIA B (Lesión
incompleta)
- Aspecto respiratorio: Traqueostomía.
Weaning dificultoso 2° a lesión cervical.
- Lesiones por decúbito: Úlcera por presión
en región sacra grado 4. Escarectomía
- Aspecto nutricional: Íleo adinàmico. Se
realiza gastroyeyunostomía .
Derivaciòn a tercer nivel .
Discusión: Paciente manifiesta expresa voluntad de poner
fin al soporte vital. Evaluado por el servicio de psiquiatría . Lucidez y
juicio conservados .
Incapacidad del círculo familiar para decidir
el retiro de soporte .
Barreras para la implementación de la
extubación terminal.
Conclusiones: De lo expuesto anteriormente , se desprende
que ; AUN contando con : Diagnóstico certero de terminalidad , voluntad
manifiesta y expresa de paciente en pleno estado de lucidez , círculo familiar
continente , servicio de salud completo especializado y capacitado en una
institución de alta complejidad , no fue posible el retiro de soporte.
La propuesta es hacia la reflexión. ¿En qué
eslabón fallamos? En qué parte del proceso nos vemos, sencillamente, impedidos
de actuar?
“Los principios éticos son criterios
normativos de conducta, que introducen la garantía de una racionalidad
argumentativa en la toma de decisiones, pero por sí solos son insuficientes.
Los conflictos que surgen en el final de la
vida, suponen un razonamiento práctico acerca de pacientes determinados, casos
específicos y situaciones únicas“.
0375 TROMBOCITOPENIA TROMBÓTICA
INMUNE INDUCIDA POR LA VACUNA (VITT) ASTRAZENECA - Reporte de caso
E Viscarra(1), G
Tajes(1), L Del Tiempo(1), M Magrini(1), E Choque(1), N Segura(1), A Santa
Maria(1), M Berté(1), D Noval(1), S Ilutovich(1)
(1) Sanatorio De La Trinidad Mitre.
La vacunación contra COVID-19 ha controlado
la pandemia, sin embargo, se han
reportado casos aislados de síndrome protrombótico en personas que recibieron vacunas
AstraZeneca y Johnson&Johnson.
Paciente femenina de 30 años, obesa,
tabaquista y con trastorno límite de personalidad; vacunada contra COVID-19.
Internada después de 14 días de administración de vacuna AztraZeneca, por dolor
abdominal, fiebre y vómitos de 72hs de evolución, cursando además 6º día de
infección por COVID 19 en seguimiento ambulatorio.
Ingresó hemodinámicamente estable, afebril,
con regular mecánica ventilatoria y abdomen distendido y doloroso en forma
generalizada. Se le realizaron laboratorios que informaron Gb 19900, Plaq
30300, TP 54%, Fibrinogeno 148, DD 217 mcg/ml, Bicarbonato 16, Lactato 5.6 y
tomografía abdominopélvica que evidenció líquido libre, esplenomegalia, edema
periportal, alteración de planos grasos adyacentes a asas intestinales y
cambios inflamatorios en mesenterio. Ingresó a UCI por shock con requerimiento
de intubación orotraqueal, conexión a asistencia respiratoria mecánica, administración
de protocolo de transfusión masiva y vasopresores. Se realizó ecodoppler
abdominal evidenciando trombosis portal y paracentesis diagnóstica con
obtención de líquido hemático. Se procedió a cirugía de urgencia en dos tiempos
constatándose líquido hemorrágico en cuatro cuadrantes y necrosis amplia del
yeyuno. Se reseca el mismo y se realiza enteroenteroanastomosis. El factor V de
Leiden fue heterocigota para nucleótido 1691 (con mutación de un alelo) y el
gen de la protrombina 20-210 fue no detectable. Se interpreto cuadro como
isquemia mesentérica secundaria a probable trombocitopenia trombótica inmune
inducida por vacuna AstraZeneca, se trató con gammaglobulina, pulsos de
metilprednisolona y anticoagulación con Rivaroxabán. Posteriormente se extubó y
fue dada de alta a los 24 días de su ingreso.
VITT es un síndrome extremadamente raro,
causado por anticuerpos que reconocen el factor plaquetario 4, que son
moléculas de inmunoglobulina G que activan las plaquetas a través de los
receptores plaquetarios FcγIIa, estimulando el sistema de coagulación y
generando complicaciones tromboembólicas.
Imita fuertemente la trombocitopenia inmune
inducida por heparina. Es importante sospecharlo en individuos que presentan
trombosis o trombocitopenia 5 a 30 días después de la administración de las
vacunas AstraZneca o Johnson&Johnson a fin de realizar el tratamiento
temprano y oportuno.
0376 TROMBOSIS CEREBRAL
RETARDADA COMO COMPLICACION DE MENINGITIS POR S. PNEUMONIAE
DF Párraga(1), G
Monti(1), C Llerena(1), G Gaudenzi(1), M Rolando(1), J Quiroz(1), K Banzer(1),
O Ferrufino(1), M Mansur(1), F Perez(1), K Gamarra(1), A Canchila(1), A
Fernandez(1), A Gonzales(1), D Mingoni(1)
(1) Central San Isidro.
Introducción: Complicación vascular en aproximadamente 8% a
22% de los pacientes con meningitis bacteriana, planteando un abordaje
terapéutico precoz a fin de mejorar la morbimortalidad asociada. Vale recalcar
que fue escrito por primera vez por Ribes en 1825, en neonatos.
Caso clínico: Masculino de 32 años con antecedente TCE
severo, craniectomía descompresiva, con recolocación de plaqueta ósea frontal,
epilepsia post-traumatica. Consulta en mayo del 2022, con cuadro de cefalea, a
las 24 horas posteriores evoluciona con agitación psicomotriz, deterioro del
sensorio, convulsiones tónico clónicas, con requerimiento de IOT/AVM,
tomografía encefálica sin hallazgos patológico agudos, punción lumbar de
aspecto turbio, hipoglucorraquia, recuento celular 6400 mm3, predominio PMN
87%. Inicia tratamiento con cefalosporina de 3ra generación, reporte
bacteriológico de S. Pneumoniae en cultivo de LCR. Destete de la ventilación
mecánica dificultoso por delirium hiperactivo, manejo conjunto por
infectología, se plantea RMN ante posibilidad de complicaciones por infección
por S. Pneumoniae; al 8vo día de asistencia ventilatoria se logra extubación
exitosa. Pase a sala de clínica médica, se realiza Angio-RNM: ausencia de señal
de flujo en tercio medio y distal del seno transverso derecho, podría
vincularse con la sospecha clínica referida a la orden medica trombosis.
Paciente se fuga sin completar tratamiento según diagnóstico.
Discusión: Patología con desarrollo de eventos
cerebrovasculares asociada con mala evolución, secuelas neurológicas y alta
mortalidad. La etiopatogenia sigue siendo poco conocida, sin embargo, se
describe que lesiones vasculares inflamatorias, conducen a un estado de
hipercoagulabilidad que puede llevar a la formación de trombos. El término
“trombosis cerebral retardada” fue introducido por Schut et al.
Conclusión: Considerar complicaciones asociadas a
infección por S. Pneumoniae, para diagnostico oportuno y precoz. Aunque el
pronóstico neurológico en los casos de meningitis asociada a Trombosis de Seno
Venoso Cerebral es malo, a continuación se presenta el caso de un paciente que
durante su internación llevaba evolución favorable.


G Fagalde(1), C
Chavez(1), L Ramasco(2), S Gabriela, R Alejandra(1), J Paula(1), C Paula(1), P
Hugo(1), T Rubén(1), PC Pablo(1), R Magdalena(1), C Ezequiel(1)
(1) Niño Jesús. (2) Sanatorio 9 De
Julio-niñojesús.
La transposición de grandes arterias (TGA) es
un defecto cardíaco grave, donde se produce una disposición anormal de los
principales vasos sanguíneos que salen del corazón. Constituyen entre el 5 y 7
% de todos los defectos cardíacos congénitos y afecta principalmente a varones.
Se desconoce la causa del defecto.
Caso clínico 1: Paciente que ingresa con diagnóstico de TGA.
Con 5 días de vida se realiza cirugía de Jatene para corrección. Tiempo de CEC
158 minutos, Tiempo Clampeo Aortico:120 min. Al ingreso UCIP presenta: tórax
abierto y contenido con sangrado masivo que requiere reintervención de urgencia
a las 4 hs. Continua en ARM con drogas Inodilatadoras, Vasopresores, Sedantes,
Analgesia y Diureticos. A las 72 horas cierre de tórax. Al 4to día
posquirúrgico presenta NEC, resuelve con tratamiento médico. Alimentación
parenteral por 10 días. En ARM durante 7 días y Cánula de alto flujo por 12
días luego de extubación programada.
Caso Clínico 2: RNT, 38 SEG, peso 3.100 gr, con controles
prenatales inadecuados. En Maternidad se diagnostica DTGA con SIV íntegro, FOP
restrictivo con infusión de prostaglandinas, noradrenalina. Se realiza
septostomía a las 48hs en Hospital de Niños, donde se realiza septostomia
auricular con balón de Rashkind siendo exitosa y sin complicaciones. Posteriormente
se realiza cirugía correctora de transposición de grandes vasos. Pasa a UCCCV
con tórax abierto y contenido. Tiempo de CEC 238min, Tiempo de clampeo Aortico
186. A las 72 hs se cierra torax y se extuba 7 dias posteriores. Recibe 15 días
de APT. 6 días de drogas Inodilatadores y vasopresores.
Conclusión: La cirugía correctora de la TGA se presenta
como una de las más complejas de resolver según clasificación de Rachs. Tiene
buena evolución con sobrevida de hasta 96%. Presentamos los 2 primeros pacientes
operados en la Provincia de Tucumán uno en una Institución Privada y el segundo
en Hospital Público. El equipo quirúrgico y el equipo de recuperación
cardiovascular fueron los mismos. Somos un equipo multidisciplinario con 6 años
de trabajo permanente en recuperación cardiovascular y con aumento constante de
la complejidad con el objetivo de resolver la mayor cantidad de cardiopatías
congénitas en la provincia.
R Ronchi(1), O
Ortiz(1), MS Ríos(1), D Murillo(1), L Vargas Ruiz(1), K Tapia Alvarez(1), S
Fernández(1), L Tumino(1), MG Sáenz(1), C Loudet(1)
(1) San Martín De La Plata.
Introducción: A partir de la publicación del estudio
ANDROMEDA-SHOCK, realizado en 5 países de Latinoamérica, la reanimación del
shock séptico guiada por relleno capilar comenzó a implementarse y a
extenderse, estando entre las recomendaciones de las últimas guías de la
“Campaña sobreviviendo a la Sepsis”. Siendo una técnica sumamente sencilla a
realizarse en la cabecera del paciente, cobra relevancia estandarizarla y que
sea bien aplicada por todo el personal que asiste al paciente crítico, en
particular de enfermería.
Objetivos: Comparar la concordancia en la manera de
realizar la medición de relleno capilar entre residentes de enfermería en
cuidados críticos del adulto.
Métodos: Corte transversal. Tres operadores realizaron
la medición consecutivamente en los mismos pacientes, y un cuarto operador
registró las mediciones. Una semana antes de realizar las mediciones fueron
entrenados para estandarizar la técnica (Fig 1). Se realizó con portaobjetos de
vidrio y el tiempo fue cronometrado. Además, se registró de los pacientes sexo,
edad, presencia de vasopresores y dosis al momento de la medición. Para
analizar registros se realizaron comparaciones entre los tres y de a duplas;
considerando relleno capilar alterado cuando era mayor de 2.5” para ser más
estricto con el margen de error. Se consideró Test Kappa “bueno” >0.4.
Análisis realizados con STATA 15.0.
Resultados: Se realizaron 72 mediciones en 24 pacientes:
66% masculino, edad 50±18, vasopresores 30%. El Test Kappa considerando los
tres operadores fue 0.50, entre el operador 1 y 2 0.43 (concordancia 83%);
entre el operador 1 y 3 0.63 (concordancia 91.7%) y entre el operador 2 y 3
0.50 (concordancia 83.3%).
Conclusiones: El desempeño en la realización del test
resultó en valores Kappa considerados como “buenos” en todas las comparaciones,
considerándose que el entrenamiento resultó adecuado, lo cual permitirá mejorar
más aún la técnica y extenderla a todo el personal de enfermería.

A Bárbara(1), P
Reyes(2), MH Fernández Darritchon(2), P Longo(2), AJ Siaba Serrate(2), S
Torres(2), T Iolster(2)
(1) Universitario Austral. (2) Hospital
Universitario Austral.
El trasplante haploidéntico de células
hematopoyéticas es una terapia potencialmente curativa para una amplia variedad
de patologías, entre las que nombramos en primer lugar por frecuencia la
leucemia linfoblástica y mieloblástica, linfomas, tumores sólidos,
inmunodeficiencias y otros trastornos.
Si bien muchas veces es la única alternativa
terapéutica, está asociado con alta tasa de complicaciones y mortalidad, las
cuales son mayores en el primer año posterior al trasplante debido a la
toxicidad de las drogas y la carga de inmunosupresión, y por sobre todo durante
la internación del paciente en unidad de TAMO.
Varias son las condiciones a valorar al
momento de su indicación. El estatus de enfermedad del paciente, el tipo de
donante, el esquema de acondicionamiento, las comorbilidades previas
condicionan la evolución y resultados. Existen escasos estudios que describen
la incidencia de las complicaciones inmediatas al trasplante en la unidad de
TAMO.
El objetivo es describir las complicaciones y
la morbi mortalidad posterior al trasplante de médula ósea haploidéntico en
pacientes de 0 a 18 años en entre 2017-2022 en la unidad de trasplante de
médula ósea del Hospital Universitario Austral.
Método: Estudio observacional retrospectivo
Resultados: Se evaluó un número mayor a 30 trasplantes
haploidénticos distribuidos de forma equitativa entre pacientes masculinos y
femeninos. Como hallazgo encontramos la mucositis y la sepsis como las dos
complicaciones más frecuentes. La ventilación mecánica prolongada se asocia a
mayor mortalidad de forma significativa junto con la terapia de reemplazo
renal.
0380 Reporte de caso:
Insuficiencia hepática secundaria a amiodarona
CM Mena(1), PL
Medici(1), A Bottaro(1), M Enriquez Gentile(1), LC Martinez Rigo(1), MA
Nogueira(1), JE Gonzalez Rapana(1), C Assali(1)
(1) Hiemi.
Introducción: La amiodarona es un antiarrítmico utilizado
frecuentemente en la Unidad de Cuidados Intensivos Pediátricos. Aunque sus
efectos secundarios están bien documentados, existen complicaciones agudas
raras que pueden pasar desapercibidas, como la hepatotoxicidad aguda y falla
renal.
Presentación del caso: Paciente femenina de 4 años de edad con
antecedente de cardiopatía congénita corregida y sin hepatopatía previa,
ingresa a Terapia Intensiva con diagnóstico de taquicardia supraventricular con
aberrancia que no responde a adenosina ni amiodarona (tres cargas de 5 mg/kg y
mantenimiento), con posterior descompensación hemodinámica y necesidad de
cardioversión eléctrica (sin respuesta).
A las 24 horas deteriora progresivamente su
función renal y hepática (Gráfico), por lo que se deriva a centro de mayor
complejidad (Hospital Garrahan) para eventual diálisis y/o trasplante hepático.
Allí se realiza ablación del haz anómalo, y se recupera función hepática y
renal con hemodiálisis. No requirió trasplante por mejoría clínica y de
laboratorio luego de la suspensión de la amiodarona. Se descartaron otras
causas de hepatopatía.
Regresa a nuestra institución por contrarreferencia
con buena evolución y posterior alta.
Discusión: Se desconoce el mecanismo de la
hepatotoxicidad por amiodarona, y resulta difícil realizar el diagnóstico
diferencial del daño secundario a isquemia, que es mucho más común (algunos autores
afirman que son la misma entidad). Podría atribuirse a la droga en aquellos
casos con rápida mejoría después de suspender la amiodarona, como en el caso
presentado.
Conclusión: La mayoría de las publicaciones sobre el tema
son en población adulta, y muestran un patrón similar de síntomas y
laboratorio, con enzimas hepáticas y bilirrubina elevados. La insuficiencia
renal grave concomitante es rara, siendo la causa más frecuente de mortalidad
en estos pacientes. Es por esto que puede resultar útil la monitorización de
estos parámetros luego de la administración de la amiodarona.
Sin embargo, la lesión hepática es
rápidamente reversible después de suspender la amiodarona y la tasa de
mortalidad es baja, por lo que no debería limitarse su uso en aquellos
pacientes que tengan clara indicación de la droga.

0381 HEMORRAGIA SUBARACNOIDEA
EN PACIENTES ONCOHEMATOLÓGICOS: REPORTE DE CASOS
R Arevillca(1), P
Gomez(1)
(1) El Cruce.
Introducción: La Hemorragia subaracnoides es una entidad clínica-radiológica
aguda caracterizada por manifestaciones neurológicas y cambios en las
neuroimágenes.
HSA no aneurismática: Abarca una amplia lista
de causas menos frecuentes como malformaciones vasculares, alteraciones
hemodinámicas cerebrales, vasculopatías, neoplasias, infecciones o abuso de
sustancias, entre otras.
La HSA no aneurismatica comprende un 10%,
dentro de esta la HSA en paciente oncohematologicos es infrecuente, su
incidencia desconocida. Y esta asociado a plaquetopenia.
En la literatura científica sólo han sido
reportado informes y series de casos de hemorragias cerebrales. Existe poca
información disponible de HSA en pacientes oncohematológicos.
Objetivo: Describir la presentación clínica,
características demográficas y evolución de 2 pacientes oncohematológicos con
HSA secundaria a plaquetopenia internados en Hospital El Cruce en el año 2022.
Desarrollo: Ambos pacientes con diagnostico de leucemia
mieloide aguda que se encontraban realizando quimioterapia presentaron
manifestaciones clinicas distintas, pero con una tomografia de hemorragia
subaragnoidea, pasaron a terapia intensiva, uno resolvio síntomas antes de las
48 horas, evolucionaron favorablemente.
Discusión: Las hemorragias en oncohematológicos son
especialmente graves. Entre los factores encontramos la asociación de
plaquetopenia durante la fase de pancitopenia e hipertensión arterial
A diferencia de lo que sucede en
inmunocomprometidos, el manejo de estos pacientes es casi exclusivamente
sintomático, ya que suelen presenter una o más contraindicaciones para la
cirugía (plaquetopenia, coagulopatia, inmunodeficiencia).
Conclusiones: A diferencia de lo reportado en la
literatura, esta serie de casos solo se centra en pacientes con patología
oncohematológica; sin embargo han demostrado un comportamiento clínico e
imagenológico similar.que inician tratamineto con quimioterapia para posterior
trasplante de médula ósea.
En la evolución, los 2 pacientes requirieron
pase a unidades de cuidados intensivos, los 2 evolucionaron con recuperación ad
integrum con tratamiento conservador, requirieron transfusión de plaquetas con
objetivo mayor a 50.000/mm3.


M Garcia
Sarubbio(1), MA Mazzoleni(1), MJ Meschini(1), C Colavita(1), V Aramendi(1), A
Barbieri(1), C Paez(1), V Pazos(1), MC Marchena(2), MG Sáenz(1), S Tal
Benzecry(1), CI Loudet(1)
(1) Higa Gral San Martin. (2) Higa Gral San Martin.
Introducción: El alto consumo de antimicrobianos (ATM) en
las UCIs es un factor contribuyente a la emergencia de resistencia. Conocer la
situación local después de un período extraordinario de pandemia por Covid 19,
puede colaborar en la definición de intervenciones de mejora en el marco de la
renovación del programa de optimización (PROA).
Objetivo: Medir indicadores de utilización de
antimicrobianos en una UCI de adultos.
Materiales y métodos: Estudio descriptivo observacional prospectivo
entre enero y junio de 2022 en una UCI médico quirúrgica de 20 camas de un
hospital de alta complejidad. Se incluyeron pacientes consecutivos ingresados a
UCI (≥ 48 hs). De las prescripciones electrónicas se extrajeron los datos de
dosis a 28 días. Se registraron características de pacientes y se determinaron
los consumos del período en dosis diarias definidas (DDD)/1000 días-paciente
(DP), los días totales de tratamiento (DOT)/1000 días-paciente, los días libres
de ATM totales y divididos en cuartiles de 7 días, el porcentaje de pacientes
que usaron cada ATM y los más consumidos. Los datos se expresaron de acuerdo a
su naturaleza.
Resultados: En el periodo ingresaron 218 pacientes ≥ 48
hs. Sus características se observan en Tabla 1; 141 usaron ATM. Indicadores:
DDD/1000 DP: 1866,90 y DOT/1000 DP: 1425,70. Los ATM más consumidos de acuerdo
a DDD y % fueron: Colistin 696,55 (16 %),Cefepime 695 (16%), Meropenem 462
(10%), Cefazolina 396 (9%), Vancomicina 390,4 (9%), Tazonam 322,5 (7%). Los
días libres de ATM (a 28d): 2 [0-5], Cuartil 1: 2 [0-3], Cuartil 2:1 [0-7],
Cuartil 3:3 [1-5], Cuartil 4:8 [4-12]. ATM más prescriptos: colistin 65%,
tazonam 58%, vancomicina 51%, cefepime y meropenem 40 % y cefazolina 15%.
Conclusión: Se observa una población con alta severidad
de ingreso, requerimiento de ventilación mecánica y estadía prolongada en UCI.
El 65% requirió ATM; los más consumidos fueron colistin, cefepime y meropenem,
los más prescriptos fueron colistin, tazonam, vancomicina, meropenem y
cefepime. La mediana de días libres de ATM fue de 2. El seguimiento con
indicadores estandarizados permite analizar futuras decisiones, más aún en
contextos de pandemia/post pandemia.

0384 Trasplante Hepático con
donante vivo: Una oportunidad creciente
J Castro Méndez(1),
P Reyes(1), I Malla(1), M Fauda(1), T Iolster(1), AJ Siaba Serrate(1), S
Torres(1)
(1) Hospital Universitario Austral.
Introducción: El trasplante de hígado de donante vivo
(LDLT) es una opción cada vez más utilizada para resolver la escasez de órganos
fallecidos en pacientes pediátricos con enfermedad hepática en etapa terminal
(ESLD), errores congénitos del metabolismo o tumores hepáticos.
Objetivo: Reportar sobrevida y evolución de pacientes
con donante vivo en un programa de trasplante Hepático de un Hospital de alta
complejidad.
Población y Métodos: Se revisaron retrospectivamente las historias
clínicas digitales de los receptores pediátricos de TH entre 2001 y 2021 y se
analizaron los resultados en supervivencia, complicaciones y duración de la
estancia hospitalaria con el programa STATA 10.0, comparando Donante vivo
contra donante cadavérico.
Resultados: Sobre 217 pacientes trasplantados, con 52% de
mujeres, mediana de edad 15 meses (R:28 dias-17 años) y mediana de peso 9kg (R:
2-66kg), tuvimos una mediana de seguimiento post trasplante de 23 meses (R:
12meses-18 años), el diagnóstico más frecuente fue Atresia de vías biliares
57%, Falla hepática aguda 18%, Cirrosis 10% entre las principales causas.
Conclusión: En nuestra serie, aunque el grupo LDLT mostró
más complicaciones vasculares y biliares (estadísticamente no significativas)
relacionadas con los receptores más jóvenes y de menor tamaño en este grupo,
tuvieron una mejor supervivencia (estadísticamente no significativa) y un
tiempo de UCI y hospitalización global similar.
LDLT es una excelente opción y proporciona
buenos resultados para pacientes pediátricos con ESLD en el escenario de
escasez de órganos.
P Melchiori(1), D
Abila(1), E Guerrero(1), P Bucciarelli(1), C Santilli(1), H Rothe(1), P
Brenzoni(1)
(1) Hospital Universitario Austral.
Introducción: Nivolumab es un inmunomodulador utilizado
para el tratamiento de Melanoma, el cual se asocia a eventos adversos
relacionados con el sistema inmunitario (irAE).
Caso clínico: Paciente masculino de 71 años que recibe
primer ciclo de Nivolumab (480mg) por diagnóstico de Melanoma. 4 días después
se presenta con astenia y dolor generalizado. Al ingreso los datos de
laboratorio revelan GOT 482 U/L, GPT 339 U/L, LDH 1144 U/L, ProBNP 178 pg/mL,
CK 1776 U/L, Aldolasa sérica 49 U/L y Troponina T hs 1955 pg/mL (TnT-hs) . Se
decide su internación en UCO por sospecha de miocarditis tóxica. El paciente no
presentaba antecedentes de angina ni ICC. Los estudios de Ecodoppler Cardiaco
Color, Resonancia Magnética, y Radiografía de Tórax no mostraron hallazgos patológicos.
Los valores elevados de TnT-hs generaron sospecha bioquímica de falsos
positivos por interferencias analíticas con anticuerpos heterófilos o complejos
de macro-troponina. Ante esto, se realizaron diferentes diluciones en el suero
del paciente (TABLA 1). Los resultados obtenidos no mostraron cambios en el
orden de los valores. Para comprender el estado cardíaco del paciente, se midió
Troponina I hs (TnI-hs) en diferentes muestras evidenciando valores aumentados.
La evolución cronológica de resultados de laboratorio del paciente se muestran
en la TABLA 2.
Discusión: No se pudo poner en evidencia la presencia de
interferencias analíticas en la determinación de TnT-hs. El aumento de TnI-hs
acompaña la sospecha de miocarditis tóxica, aunque los estudios de imágenes no
evidencian alteraciones significativas. Los valores elevados de transaminasas,
CK y Aldolasa sugieren el diagnóstico de hepatitis y miositis tóxica,
respectivamente. Luego de 2 meses y con la posterior administración de
corticoides, los niveles de CK, transaminasas y TnI-hs disminuyeron, por el
contrario, los niveles de TnT-hs permanecieron elevados.
Conclusión: Es de suma importancia abordar el diagnóstico
de forma multidisciplinaria, conocer los efectos adversos de estas drogas y
tener presente posibles interferencias analíticas de tal forma de descartarlas
o reforzar la idea de un daño real, para poder brindar una atención rápida a
pacientes con cardiotoxicidad debido a su alta tasa de mortalidad.


0386 CONSUMO DE ANTIMICROBIANOS
EN UNA UNIDAD DE CUIDADOS INTENSIVOS DE ADULTOS
M Garcia
Sarubbio(1), MA Mazzoleni(1), MJ Meschini(1), C Colavita(1), V Aramendi(1), A
Barbieri(1), CE Páez(1), V Pazos(1), MC Marchena(2), MG Sáenz(1), S Tal Benzecry(1),
A Garroni(1), CI Loudet(1)
(1) Higa Gral San Martin. (2) Higa Gral San Martin.
Introducción: El uso inapropiado de antimicrobianos (ATM)
en unidades de cuidados intensivos (UCI), donde existe alta prevalencia de
infección por gérmenes multirresistentes (MOR), puede derivar en aumento de
morbilidad, mortalidad y costos hospitalarios. Revisar la evolución de nuestro
patrón de uso a lo largo de los últimos años es un importante nivel de análisis
dentro de un programa de optimización de antimicrobianos (PROA).
Objetivos: Analizar el perfil de consumo de ATM entre
2015 y 2021 y comparar el costo anual de ATM a lo largo de 7 años.
Métodos: Estudio observacional de cohorte
retrospectivo en la UCI de adultos (14 camas) de un hospital de alta complejidad.
Los consumos de ATM de uso endovenoso entre 2015 y 2021 se recolectaron del
sistema de dispensación automatizada de medicamentos y se expresaron en Dosis
Diaria definida (DDD)/100 día cama ocupada (DCO). El costo en pesos se
determinó actualizado al último precio de compra, junio 2022. Se realizaron
comparaciones múltiples del consumo y costos anuales totales cada 100 DCO en
siete años para cada ATM, con Tests ANOVA o Kruskal-Wallis con ajuste
Bonferroni. Se consideró significativa p<0.05
Resultados: Se utilizaron 39 ATM diferentes; 20396
DDD/100 DCO en total. Más de la mitad del consumo global correspondió a
meropenem (18.24%), colistin (16.43%), vancomicina (11.3%) y cefepime (9.56%).
En 2021 se observó un consumo significativamente menor de piperacilina-tazobactam
y fluconazol, mayor de cefepime, cazavi, aztreonam y anidulafungina; amikacina
menor en 2015 vs 2016-2017-2020, fosfomicina fue más consumida en 2016.El resto
no presentó diferencias. El costo anual en pesos mostró tendencia ascendente en
2020 y 2021 y al ajustar por DCO resultó significativamente mayor en 2021 vs
2015, 2017 y 2018.
Conclusión: Los mayores consumos correspondieron a ATM
que no presentaron importantes diferencias en los 7 años evaluados. El aumento
en el costo asociado a mayor consumo de Cazavi/Aztreonam y anidulafungina con
la disminución de otras alternativas expone la emergencia de MOR pero a su vez
la necesidad de complementar el PROA con este tipo de análisis para planear e
implementar estrategias de mejora pertinentes.
M Pazmino(1), M
Giampieri(1), M Gonzalez(1), C Lutkevicius(1), P Castellani(1), M Rabino(1)
(1) Sor Maria Ludovica De La Plata.
Introducción: Las lesiones de las vías biliares por causa
traumática son infrecuentes en la edad pediátrica, su incidencia llega al 3% en
trauma abdominal cerrado. La secuela frecuente es el bilioma, colección
encapsulada fuera del árbol biliar. La evolución es variable incluso hasta 4
semanas del evento traumático, determinando diagnóstico tardío, aumentando la
morbilidad y estancia hospitalaria. El tratamiento puede incluir medidas
conservadoras y mínimamente invasivas.
Objetivo: Describir las características clínicas, exámenes
complementarios y evolución clínica de 2 pacientes con Trauma hepático severo y
bilioma, que requirieron Unidad de Cuidados Intensivos Pediátricos.
Descripción: Se reportan dos casos de pacientes
pediátricos masculinos de 14 años que ingresaron por traumatismo abdominal
cerrado, uno por caída y coz de caballo y otro por colisión vehicular. La causa
de ingreso prevalente fue shock hipovolémico. En ambos casos se detectó
laceración hepática grado 4, y requirieron laparotomía exploratoria, packing
hepático alrededor de 2,4 días, e inotrópicos en promedio 8 días. Permanecieron
internados con una media de 65 días, prolongando su estancia intercurrencias
infecciosas, injuria renal y bilioma. Presentaron drenajes pleurales
aproximadamente 12,4 días y peritoneales 15 días, recibieron nutrición
parenteral durante 22.4 días, lográndose rehabilitación enteral progresiva
completa a los 20 días. Necesitaron ARM 18 y 51 días, este último requirió
traqueostomía por fallos mixtos, que al alta se logró decanular.
Durante su evolución presentaron bilirragia y
derrame pleural derecho sin compromiso colestásico por laboratorio. El paciente
con menor estancia hospitalaria en control ambulatorio evidencio colección
magna (bilioma) supra-hepática segmentos VI y VII 13x7x9cm; mientras que el
otro paciente colección pequeña en segmento VII de 4x2cm, y ambos se realizaron
drenaje percutáneo, uno guiado por TAC y otro por ecografía.
Conclusiones: Laceraciones graves del parénquima hepático
asociado a lesión de vía biliar, puede incrementar el riesgo de formación de
bilioma. Solo aquellos con dimensiones mayores pueden manifestarse
clínicamente, luego de un periodo de latencia. Es una complicación rara, y
precisa alta sospecha diagnóstica en pacientes con politraumatismos que incluya
trauma abdominal. El tratamiento de elección es drenaje percutáneo guiado por
ecografía o TAC, dejando la cirugía para los casos con fuga activa y fracaso
del drenaje.


AS Piga(1), TE
Lujan(1), CS Senger(1)
(1) Clínica Modelo Sa.
Introducción: El Síndrome de Guillain Barré (SGB) es una
polirradiculoneuropatía inmunomediada usualmente precedida por una infección,
como Campylobacter jejuni, u otra estimulación inmune, como la vacunación. Se
clasifica en desmielinizante (AIDP) y axonal (AMAN).
Presentación del caso: Masculino de 42 años, trabajador rural, con
antecedente de obesidad y de vacunación para COVID 19 con 3 dosis. Consultó por
cuadro de debilidad muscular de los 4 miembros de inicio súbito, sin compromiso
sensitivo y sin síntomas previos, ingresando a UTI con debilidad facial
bilateral simétrica leve, hipofonía y disglusia; cuadriparesia; arreflexia
generalizada. Sensibilidad y función esfinteriana conservada. LCR con
leucocitos 2/mm3 y proteinorraquia 0.70 g/L; RM de cerebro sin alteraciones y
médula espinal cérvico-dorso-lumbar de morfología e intensidad de señal normal.
Por compromiso bulbar requirió ARM. Se solicitaron Ac Anti-GM1 con resultado
positivo. Se solicitó pantomografía para diagnóstico diferencial, se observó
disección aórtica con extensión hacia ambas arterias ilíacas y trombosis de la
arteria ilíaca externa y femoral izquierda, se anticoaguló. Se realizó
electromiografía que informa polineuropatía axonal a predominio de miembros
inferiores. Inició plasmaféresis, realizó 7 sesiones, y posteriormente
inmunoglobulina G EV 2 g/kg sin mejoría clínica, se derivó al paciente a centro
de rehabilitación.
Discusión: El SGB puede ser un trastorno complejo de
diagnosticar y manejar. Nuestro paciente cumplía con los criterios clínicos, bioquímicos,
electromiográficos y dosaje de anticuerpos anti-GM1. Se realizaron numerosos
diagnósticos diferenciales al ingreso del paciente: encefalitis y eventos
vasculares, descartado por RM; mielitis transversa, infiltración medular o
síndrome paraneoplásico, no se evidenciaron alteraciones medulares en RM, ni
tumores en cerebro, tórax, abdomen o pelvis; enfermedad de Lyme, presentaba
patrón axonal, pero anticuerpos Anti-Borrelia burgdorferi negativos; miastenia
gravis, botulismo y síndrome de Eaton-Lambert, no compatible con
electromiograma.
Conclusión: Destacamos que luego de la búsqueda de
posibles desencadenantes no se pudo encontrar etiología concreta; y el segundo
punto a resaltar es la instauración súbita de los cuadriparesia. A pesar del
tratamiento actual, nuestro paciente persiste con secuelas discapacitantes.
R Retambay(1), RR
Reinoso(1), NS Llanes(1)
(1) San Bernardo.
Introducción: Un accidente cerebrovascular (ACV) ocurre
cuando el suministro de sangre a una zona del cerebro se ve gravemente
comprometido.
Documentada como la tercera causa de muerte y
la primera causa de discapacidad en la Argentina. Los eventos isquémicos
constituyen el 80% de los casos del total de eventos cerebro vasculares.
Presentación del caso: Paciente de sexo femenino de 20 años,
antecedentes de consumo de ACO y poliquistosis ovarica, consulta por
hemiparesia braquiocrural izquierda, se realiza TC de cerebro que evidencia
borramientos de surcos a nivel temporal derecho, ASPECT 10, Ingresa a Unidad de
Stroke con NIHSS 6, con tiempo puerta-aguja de 30 minutos, se inicia infusión
de rtPA, según protocolo (2 hs 30 de inicio de síntomas). Durante el mismo
presenta aumento de NIHSS a 13, se realiza AngioTC constatándose oclusión de M2
derecha, se decide Trombectomía con tiempo imagen-punción de 60 minutos (5 hs
de inicio de síntomas) obteniéndose resultados favorables con TICI 2b.
Cursa internación en UTI durante 48 hs, pasa
a sala con sospecha de SAF, previo al alta se realiza RNM que evidencia imagen
parieto temporo insular izquierda y en cabeza del caudado izquierdo,
hiperintensa en FLAIR y DWI, hipointensa en ADC, compatible con isquemia.
Egreso hospitalario con Rankin 1.
Discusión: La evidencia sugiere que la trombectomía ante
fallo en trombolisis sistémica es una práctica segura, aunque el presente caso
requería tratamiento combinado inicial, se obtuvo buena respuesta ante
tratamiento diferido. La incidencia de ACV isquémicos es mas frecuente en
pacientes mayores de 55 años, la baja prevalencia en jóvenes obliga a estudiar
causas alternativas, siendo en este caso TOAST 4.
Conclusión: La importancia del monitoreo continuo y la
rapidez en la toma de decisiones demostró mejorar la morbilidad en esta
patología, como se ve en el caso en donde la paciente no presentó déficit
funcional a pesar de la evidencia de compromiso en la IRM de control.


0392 Trombosis venosa cerebral
con transformacion hemorragica en Enfermedad de Wilson
L CASTIBLANCO(1), YR
AREVILLCA(1), I PEÑA CECCONI(1), J NAVIA(1), C RODRIGUEZ(1), D SANCHEZ(1), Y
SAAD(1)
(1) Hec.
Introducción: La trombosis venosa cerebral representa el 1%
de las enfermedades cerebrovasculares. Puede afectar a cualquier grupo etario,
aunque es más frecuente en jóvenes. Clínicamente puede presentarse como
cefalea, alteraciones visuales, trastornos del lenguaje, déficit motor y/o
sensitivo, pudiendo observarse infartos venosos y/o hemorragias cerebrales. Su
relación con la Enfermedad de Wilson no está un descripto.
Caso Clínico: Paciente de 23 años con antecedente reciente
de neumonía por SARS CoV2 quien consultó a un servicio de guardia por síndrome
ascítico edematoso con alteración del hepatograma en dos oportunidades,
evolucionó con falla renal requiriendo terapia de reemplazo renal y luego
presentó foco motor neurológico. Se realizó TC de encéfalo que evidenció
hemorragia parietal derecha, se completó el estudio con RMN con contraste que
identificó trombosis del seno venoso transverso.
Persistió con alteraciones del hepatograma y
signos de hipertensión portal por lo que, entre otras determinaciones, se
realizó dosaje de ceruloplasmina, que se encuentraba disminuida; y cobre, que
se encuentraba elevado; por lo que se llega al diagnóstico de Enfermedad de
Wilson.
Discusión: Este caso presentó un desafío diagnostico ya
que no existe una relación clara entre la enfermedad de Wilson y la trombosis
del seno venoso.
Ante un cuadro clínico que afecta diferentes
órganos y sistemas que no son congruentes, tenemos la obligación de continuar
con el estudio etiológico persiguiendo la unicidad al momento de plantear los
diagnósticos diferenciales.
0393 PREVALENCIA DE DISFAGIA EN
PACIENTES INTERNADOS EN UNIDAD DE CUIDADOS INTENSIVOS
J Soria(1), M
Singh(1), F Am(1), J Moreno(1), S Ramos(1)
(1) Sanatorio San Roque.
Introducción: La disfagia ha sido reconocida por la OMS como
una discapacidad y esta asociado con un aumento de la morbilidad, mortalidad y
los costos de atención. Estos pacientes tiene alto riesgo de desnutrición o la
misma puede estar presente desde el inicio de internación. La principal
prioridad es realizar oportunas modificaciones dietéticas para evitar la
aparición de complicaciones y ayudar a la rehabilitación.
Objetivos: Determinar la incidencia de disfagia en
pacientes de terapia intensiva del Sanatorio San Roque durante mayo-julio del
2021.
Materiales y métodos: estudio cuantitativo descriptivo de corte
transversal. Se evaluaron 95 pacientes mediante examen físico al ingreso, se
realizo evaluación de los musculos que intevienen en la masticación según
funcionalidad para determinar la presencia de disfagia.
Resultados: Del total (n=95), el 55% (53) corresponde a
sexo masculino. La edad más frecuente fue 60 a 80 años (61%). Con edad media de
66,1 años. El 78% presentó deglución normal sin disfagia. El 14% se encontraba
con disfagia esofágica mientras que el 11% presento disfagia con compromiso de
la fase oral. La mortalidad de los pacientes fue 16 % en los pacientes
estudiados. El 39% de pacientes con disfagia fallecieron (test de Fisher
0,0024-p o,o1).
Conclusión: La disfagia es una patología frecuente en
pacientes que ingresan a uti, afecta tanto a varones como mujeres. La
predisposición de padecer disfagia esta relacionada con la cantidad de
comorbilidades. Se observo que aquellos pacientes que padecen disfagia
presentan mayor mortalidad.


0394 DISFUNCIÓN ORGÁNICA
SECUNDARIA A CONSUMO DE MDMA
I Peña Cecconi(1), Y
Saad(1), R Arevillca Yugar(1), J Navia(1), LM Castiblanco(1), K Botana(1)
(1) Hospital El Cruce.
Introducción: El alcohol y drogas de abuso, presentan un
consumo cada vez más extendido.
El daño hepático agudo en la población joven,
una vez descartadas las hepatitis virales, el consumo de cocaína y
metanfetaminas, ocupa un lugar muy importante como factor etiológico. La
cocaína es una causa importante de daño hepático grave asociado a
rabdomiólisis. El daño hepático sin rabdomiólisis, es más frecuente como
consecuencia del consumo de metanfetaminas.
A propósito de una paciente con cuadro de
disfunción múltiple de órganos por consumo de éxtasis, marihuana y
metanfetaminas, investigamos en los diferentes medios de búsqueda bibliográfica
médica y encontramos reporte de casos.
Caso clínico: Paciente femenina de 20 años, ingresó a la
guardia por excitación psicomotriz e hipertermia. Consumo reciente de MDMA.
Se realizó laboratorio inicial que evidenció:
AKI III en contexto de rabdomiólisis, acidosis metabólica, hepatitis aguda con
aumento enzimático por 10, y coagulopatía.
Se detectó en orina: MDMA, Marihuana y
Anfetamina
Evolucionó con síndrome serotoninérgico
grave, requiere intubación orotraqueal y ventilación mecánica. Se realizó,
dosis de carga y mantenimiento de Ciprohepatidina.
Fue derivada a nuestro centro para valoración
por servicio de Hepatología con diagnóstico presuntivo de falla hepática
fulminante.
Se realizó ecocardiograma por el aumento de
la troponina ultrasensible y la presencia de trastornos de la repolarización en
cara lateral en el ECG; que descartó disfunción biventricular, FEVI 65%,
aurículas de tamaño conservado, sin signos de valvulopatía.
TAC de encéfalo sin daños estructurales; y
tórax presentó consolidación basal derecha secundaria a broncoaspiración
Discusión: El consumo de drogas de abuso es un problema
de salud creciente en el mundo, hemos encontrado solo reporte de casos de la
falla hepática secundario al consumo de MDMA.
Es nuestro compromiso compartir las
experiencias de casos similares a fin de llegar a diagnósticos tempranos y
tratamientos oportunos.
En la revisión bibliográfica realizada,
encontramos que el daño hepático secundario al consumo de éxtasis puede
presentarse asociado o no a rabdomiólisis (de aparición inmediata o más
tardía). El cuadro tardío es similar a una hepatitis aguda, las otras dos
formas de presentación se asociaron a necrosis, similar a lo que sucede con la
cocaína.
El trasplante hepático como tratamiento es
discutido en el marco del pronóstico asociado a las toxicomanías.

![]()
R Arevillca(1)
(1) El Cruce.
Introducción: Es una alteración neurológica más frecuente
relacionada al déficit de tiamina, los requerimientos diarios de vitamina B1 es
1-2 mg
La EW se ha descrito, además de en sujetos
con alcoholismo, en enfermedades tan dispares como la anorexia nerviosa, la
diálisis peritoneal, neoplasias diseminadas, la hiperémesis gravídica o en
pacientes intervenidos de cirugía gastrointestinal, nutrición parenteral
prolongada sin aporte de vitaminas.
Presentación del caso: Paciente femenino de 24 años de edad. Curso
internación en otro nosocomio por presentar pseudoquiste pancreático de 5
semanas de evolución secundaria a pancreatitis aguda litiásica, con
intolerancia digestiva asociado a náuseas y vómitos sin respuesta al
tratamiento médico. Por lo que fue derivada para resolución quirúrgica.
A su ingreso reinicia nutrición parenteral.
En el día 1 de POP de quiste-yeunoanastomosis
intercurrió con diplopía de ojo derecho, nistagmo horizontal, parálisis del VI
bilateral, posterior deterioro del sensorio Glasgow 10/15 por lo que se realiza
nueroimágenes.
Se reinterpreta diagnostico como síndrome de
Wernicke en contexto de alimentación parenteral sin suplementación de complejo
B e imágenes compatibles en la RMN de encéfalo. Inicia infusión de vitamina B.
Discusión: El tratamiento debe ser la reposición de
tiamina lo antes posible, esta evidencia no procede de ensayos clínicos
controlados debido a la dificultad para realizarlos. Por otra parte, existe
también acuerdo acerca de la conveniencia de instaurar una dieta normal lo
antes posible. la administración inicial debe ser intravenosa, y debería
mantenerse hasta la estabilización clínica
En cuanto a la profilaxis, se recomienda la
utilización de tiamina en situaciones de riesgo como son los pacientes alcohólicos,
anorexia, pacientes oncológicos o sometidos a cirugía bariátrica, Conclusión
Debemos sospechar Síndrome de Wernicke en
todo paciente con factores de riesgo o no que presenten deterioro del estado
mental alterado no diagnosticado, trastornos oculomotores o ataxia.
En pacientes con alta sospecha, iniciar
Tiamina en forma empírica por el alto riesgo de progresión a coma y muerte.

A Jora(1), C Colque
Espada(1), ME Boazzo(1), Y Juarachy(2), R Quisbert(2), Y Ramos Alcaraz(2), JC
Garcia(1), C Farias(2)
(1) Hzga Balestrini. (2) Hzga.
Las micosis sistémicas son enfermedades
graves y letales. Frecuentes en huéspedes inmunocomprometidos.
Objetivo: Descripcion de caso clinico.
Material y métodos:
Analisis retrospectivo de historia clínica: Femenina de 25 años sin antecedentes.
Cesarea 15/3/22.
Reingresa a nuestra institución 72 hs por
cesarea por presentar dolor abdominal, fiebre, secreción herida quirúrgica y
loquios fétidos.
Se realiza ecografía que evidencia endometrio
engrosado con colección en sitio quirúrgico.
Se realiza histerectomía subtotal + lavado de
cavidad. Inicia tratamiento antiobiótico empírico con gentamicina/clindamicina,
se toman cultivos con rescate bacteriológico s.Hominnis, s. Viridans, s.
Lugdunensis. Se rota antibiótico a piperacilina/tazobactam por evolución
tórpida.
Ingresa a uci
con diagnóstico de sepsis puerperal.
Tac tórax/adbomen y pelvis infiltrados pulmonar
bilaterales, uronefrosis, colección supravesical, conducta espectante.
Dia 9: Ecografía colección 50 mm x 18 mm
flanco derecho se realiza punción y evacuación, debito purulento.
Febril persistente se reitera tac de abdomen: uronefrosis + líquido
libre a nivel pelviano, laparotomia exploradora + histerectomia total +
salpinguectomia sub total drenaje de abceso + apendicectomía + lavado de
cavidad abdominal.
Inicia empíricamente meropenem, vancomicina,
colistin + fluconazol por candida score elevado.
Resultado de cultivo en liquido
abdominal/piel y partes blandas:
aspergillus.
Se rota a anfotericina liposomal.
Conclusion: Se presenta dicho caso clínico para describir
la evolución y clínica de un patógeno con baja prevalencia en cavidad
abdominal.
AN Pérez Murúa(1), M
Jaume(1), MF Piñeiro(1), MP Cordero(1), D Lafosse(1), A Tristaíno(1), L
Pero(1), B Castro(1), D Dobricich(1), K Cisneros(1), E Porjolovsky(1), L
Franconieri(1)
(1) Sanatorio Antártida.
Introducción: Chryseobacterium indologenes es un bacilo
gram negativo no fermentador (BGNNF) pigmentado intrínsecamente resistente a
carbapenemes. En los últimos años fue descrito como causante de infecciones en
huéspedes inmunocomprometidos, incluída neumonías asociadas a ventilación
mecánica (NAVM). Su comportamiento como germen emergente, obliga a considerarlo
en población susceptible.
Presentación del caso: Paciente masculino de 64 años, ex-tabaquista,
EPOC, síndrome de impregnación, y diagnóstico reciente de adenocarcinoma
pulmonar, en plan de tratamiento oncoespecífico. Ingresa con cuadro de neumonía
grave por H. Influenzae, requiriendo asistencia ventilatoria mecánica (AVM). Al
día 5, intercurrió con shock séptico y criterios de NAVM. Inició tratamiento
antibiótico con Vancomicina, Imipenem, Colistin. En 48 hs, se documenta en
aspirado traqueal S. aureus meticilino-sensible y una colonia de (BGNNF) con
pigmentación amarilla, también presente en hemocultivos. Se ajustó esquema a
cefazolinacolistin. A las 72 hs, sin obtener respuesta clínica, se toman nuevos
cultivos, desarrollando en hemocultivo de BGNNF pigmentado identificado como
Chryseobacterium indologenes. Se agregó TMS monoterapia, evolucionando
clínicamente favorable sin recaída microbiológica. Finalmente, cursó nuevo
evento de NAVM con hipoxemia refractaria y óbito.
Discusión: C. indologenes, es un germen emergente. Es
intrínsecamente multirresistente y puede generar biofilm. En nuestro paciente,
al no tener respuesta clínica inicial y persistiendo la bacteriemia, se decidió
su tratamiento con resultado exitoso.
Conclusió: C. indologenes constituye un posible agente
etiológico de NAVM, especialmente en paciente inmunocomprometidos. La presencia
de colonias de BGNNF con pigmentación amarilla debe alertar tempranamente de su
presencia. Su perfil de amplia resistencia antimicrobiana obliga a considerar
al TMS como una opción terapéutica.

0398 MEDIASTINITIS POST
CINECORONARIOGRAFIA
EM Choque Ortiz(1),
G Tajes(1), E Viscarra(1), A Santa Maria(1), M Berté(1), N Segura(1), D
Noval(1), S Ilutovich(1)
(1) Sanatorio De La Trinidad Mitre.
El cateterismo cardíaco es un procedimiento
invasivo que se utiliza con fines diagnósticos y terapéuticos. Entre las
complicaciones más frecuentes se encuentran las vasculares, que ocurren en el
0.43% de los procedimientos. El hematoma mediastinal es una complicacion muy
rara.
Se presenta el caso de paciente masculino de
75 años, con antecedente de estenosis aórtica severa sintomática, en plan de
implante percutáneo de válvula aórtica. Internación reciente en otro centro
donde se realizó cinecoronariografía por vía radial, sin evidencia de patología
coronaria, evoluciona post procedimiento inmediato con dolor de pecho, por lo
que se estudió con Tomografía y Resonancia Magnética de tórax donde se constató
masa mediastinal, por sospecha de tumor se realizó biopsia transbronquial
obteniendo material hemático. Se otorgó alta sanatorial.
Consulta a este centro una semana después,
por cuadro clínico de disnea CF IV, fiebre y dolor torácico de 48 horas de
evolución, normotenso. Evaluado por Servicio de Cardiología, descartan
patología coronaria y aortica. Los exámenes de laboratorio mostraron Gb 15.600
mm3; Urea 96 mg%; Creatinina 1.3 mg%; Bilirrubina total 4.1 mg%; Procalcitonina
24 ng/ml. TC de torax con contraste endovenoso se constató imagen hipodensa
mediastinal con burbujas aéreas. Por insuficiencia respiratoria progresiva se
solicita pase a Unidad de Cuidados Criticos.
Evoluciona con shock septico y falla orgánica
múltiple con requerimiento de soporte ventilatorio, vasopresor y hemodiálisis.
Desarrolla neumotorax por lo que se coloca tubo pleural evacuándose líquido
purulento en contexto de empiema pleural. Se procede a realizar toracoscopía
con decorticación pleural y toilette mediastinal. Recibe antibioticoterapia
dirigida a Streptococcus Anginosus. Intercurrió con fístula broncopleural
resuelta espontaneamente. Evolucionó favorablemente, corrigiendo disfunciones
orgánicas, con extubación exitosa y posterior egreso Sanatorial a 29 días de su
ingreso.
La efracción vascular es la ruptura de la pared
de la arteria; esta puede ocurrir por el catéter guía, utilización de catéter
de extensión o la expansión excesiva del balón o del stent.
La Mediastinitis Aguda no secundaria a
cirugía previa constituyen un conjunto de entidades clínicas muy infrecuentes
pero potencialmente mortales. En la mayoría de los casos se observan como
complicación de procedimientos quirúrgicos cardiovasculares o torácicos.
0400 PANCREATITIS AGUDA
SECUNDARIA A HIPERTRIGLICERIDEMIA SEVERA. PRESENTACIÓN DE CASO
G Garelli(1), GM
Garelli(1), JJ Storani(1), SB Soli(1), DS Diaz(1)
(1) Hospital Italiano Rosario.
Introducción: La hipertrigliceridemia es la tercera causa
después de la etiología biliar y alcohólica, y a ella se atribuye el 10% de
todos los casos. En general se presenta de forma leve, pero un 15% puede
corresponder a una forma grave, asociada muchas veces a necrosis pancreática.
Caso clínico: Mujer de 46 años, diabética tipo II con
requerimiento de insulina, dislipémica, hipotiroidea y obesa, colecistectomizada.
Ingresa por cuadro de dolor abdominal de intensidad moderada, epigástrico, y
vómitos de 48 hs de evolución. Al examen físico paciente lúcida, normotensa,
taquipneica, abdomen distendido, doloroso a la palpación, sin defensa,
descompresión negativa, RHA disminuidos. Laboratorio: GB 19500 cel/mm3,
Glicemia 435 mg/dl, Cetonemia ++, Amilasemia 300 mg/dl, Trigliceridemia 20260
mg/dl, acidosis metabólica. TAC de abdomen sin contraste: ascitis, liquido
libre periesplenico e interasas, páncreas edematoso, aumentado de tamaño,
rodeado de líquido libre en bandas que produce reticulación. Se expande con
cristaloides e inicia infusión con insulina. Agrega HTA que se controla con
NTG, tras 48 hs y con mejoría clínico-analítico inicia fibrato y estatina VO. Al
día 11 pasa a sala general con valores de TAG 590, resto de laboratorio dentro
de valores normales.
Discusión: La pancreatitis aguda es una complicación
severa de la hipertrigliceridemia, siendo las manifestaciones clínicas
similares a otras pancreatitis. El diagnóstico se realiza a través de análisis
de laboratorio e imágenes (TAC). El tratamiento incluye ayuno, hidratación con
cristaloides, analgesia, profilaxis antitrombótica y protección gástrica. La
insulinoterapia (en este caso necesario para tratar la cetoacidosis diabética)
también es útil ya que aumenta la actividad de la lipoproteinlipasa y aumenta
la degradación de quilomicrones. En casos graves que no respondan al
tratamiento médico se puede considerar el uso de Plasmaféresis.
Conclusión: La hipertrigliceridemia es una causa de
pancreatitis aguda que requiere un rápido diagnóstico, a tener en cuenta
especialmente en pacientes con mal control metabólico. Su tratamiento es, en la
mayoría de los casos conservador, siendo útil la insulinoterapia y los
fibratos, permaneciendo la plasmaféresis como tratamiento en casos aislados.
0401 PRESENTACIÓN ATÍPICA DE UN
CASO DE GUILLAIN BARRE POSVACUNACIÓN
M Teherán(2), G
Rodrigues(1), D Santos(2), S Toledo(2), J García(2)
(1) Municipal Eva Perón De Merlo. (2) Interzonal
De Agudos Dr. Diego Paroissien.
Introducción: Las polineuropatías agudas del síndrome de
Guillain Barre son usualmente gatilladas por una respuesta inmune o un
antecedente de infección o una reacción a epítopos que se comparten con los
nervios periféricos. Los principales desencadenantes suelen ser las
infecciones, antecedente de vacunación. SGB ocurre en todo el mundo con una
incidencia de 1 a 2 casos por 100000 al año. Afecta todos los grupos etareos.
Caso clínico: Masculino de 35 anos de edad sin
antecedentes, consulta por perdida de fuerza muscular en cuatro extremidades
asociado a parestesia de forma ascendente, en las ultimas 3 semanas previo a su
ingreso refiere colocación de vacunas (hepatitis B, influenza y moderna COVID
19) el cual evoluciona rápidamente con insuficiencia respiratoria mixta, se
decide intubación orotraqueal y asistencia respiratoria mecánica invasiva. Se
realizan tomografía de encéfalo sin alteración morfológicas y punción lumbar
que evidencia disociación albumino/citológica se inicia inmunoglobulina a
0.5g/kg/día por 5 días. Intercurre con neumonía asociada a la ventilación
mecánica, con aislamiento de proteus mirabillis y en el urocultivo una
Klepsiella pneumoniae. por lo que recibió antibioticoterapia dirigida. Por ARM
prolongada se realiza traqueostomía percutánea, se inicia weaning de la
ventilación mecánica, a las 3 semanas presenta mejoría en la fuerza muscular,
sensibilidad superficial y profunda. con la consiguiente desvinculación de la
ventilación mecánica, tolerancia a la vía oral
Conclusión: El SGB puede ser una enfermedad difícil de
diagnosticar y tratar debido a la heterogeneidad de su presentación clínica y
el pronóstico varia ampliamente entre los pacientes. Describimos el caso de un
paciente con cuadro de Síndrome de Guillain Barre post vacunación. La terapia
con inmunoglobulina IV (IVIG) o plasmaféresis (PLEX) ha demostrado efectividad,
sin evidencia de mayor efectividad de una sobre la otra.
0402 TROMBOEMBOLISMO PULMONAR
SECUNDARIO A DISECCION DE LA ARTERIA PULMONAR: A PROPOSITO DE UN CASO
MA Misa(1), A Brañez
Toro Yasmani(1), DC Rodriguez(1), CL Landoni(1), A Brizuela(1), JP Soliz(1), J
Vazquez(1), S Roldan Montaño(1), A Luzzi(1), J Lescano(1)
(1) Sanatorio Julio Mendez.
Introducción: El SM es una enfermedad hereditaria
autosómica dominante con una prevalencia de 1: 10.000 nacidos vivos. que
compromete el tejido conectivo de varios sistemas. El diagnóstico se basa en
criterios clínicos, pero la forma de presentación es muy diversa. En este reporte
describimos un caso de presentación clínica atípica con lesión vascular aortica
y pulmonar extensa, asociada a insuficiencia respiratoria aguda por
tromboembolismo pulmonar bilateral.
Paciente masculino de 27 años sin
antecedentes patológicos conocidos, presenta sincope durante la realización de
ejercicio por lo que acude a guardia externa presentando taquipnea, saturación
de oxigeno 87%, crepitantes pulmonares bilaterales, taquicardia y disociación
de tensión arterial 130/45 mmHg. En estudios complementarios se evidencia
hipoxemia e radiográfia de tórax con radiopacidad bilateral.
Ingresa a Clínica médica con diagnóstico de
NAC. Evoluciona con insuficiencia ventilatoria e hipoxemia severa y signos de
shock. A las 24 horas se realiza TAC de tórax y se observa dilatación de la
raíz aortica, angio TC que informa disección aortica de aorta ascendente,
cayado aórtico, aorta descendente, disección de arteria carótida derecha y
arteria coronaria derecha, disección de arteria pulmonar y ambas arterias
bronquiales mas TEP bilateral. Se decide cirugía de urgencia de Bentall Bono.
Evoluciona con mejoría hemodinámica y respiratoria, se inicia anticoagulación y
es dado de alta a domicilio.
Discusión: La complicación más temida del SM es la
disección aórtica aguda. Sólo en el 1% de los casos dicha disección aortica se
acompaña de disección de la arteria pulmonar y TEP. La formación de un hematoma
mural aórtico que se extiende hacia la arteria pulmonar explica la disección de
la adventicia que recubre ambos grandes vasos. A medida que la sangre diseca
hacia las arterias pulmonares obstruye las ramas segmentarias de la arteria
pulmonar por compresión extrínseca y explica el TEP asociado. La pronta
detección del TEP asociado es fundamental para desviar el pronóstico desfavorable
de la enfermedad.
Conclusión: El diagnóstico del SM es un desafío clínico.
La disección concomitante de la arteria aortica y pulmonar es una complicación
grave muy poco frecuente y de difícil manejo clínico. La falta de experiencia dificulta
además la toma de decisiones.
M Ramon(1), M
Singh(1), N Aguer(1), F Am(1), J Moreno(1), S Ramos(1)
(1) Sanatorio San Roque.
Introducción: La desnutrición hospitalaria incrementa las
complicaciones infecciosas y no infecciosas, así como la morbilidad y
mortalidad. La evaluación del estado nutricional debe ser la primera
intervención para planificar una asistencia nutricional temprana y eficiente.
Objetivo: Determinar el estado nutricional de los
pacientes al momento del ingreso a UTI y su relación con los valores de
albumina sérica.
Materiales y métodos: Estado nutricional. Materiales y métodos Se
realizó un estudio prospectivo, descriptivo, observacional de corte
transversal, encuestándose 77 pacientes al ingreso a la unidad de terapia
intensiva, desde el 1 de mayo al 31 de julio de 2022.
Resultados: Se observó según el IMC, el 13.37 % (n = 10)
de los pacientes presentó bajo peso, el 48.83 % (n = 38) peso normal, el 36.36
% (n = 28), sobrepeso, y el 1.29 % (n=1) obesidad. El 51.94 % (n = 40) del
total de pacientes tuvo niveles de albúmina disminuidos. El 62.5 % (n = 25) de
los pacientes con desnutrición presentó niveles de albúmina entre 3.4 y 3 g/dl
y el 27.5% (n = 11), albúmina entre 2.9 y 2.1 g/dl. El 20 % (n = 8) con
desnutrición tuvo valores de albúmina por debajo del límite de normalidad. Las
variables IMC y niveles de albúmina registraron asociaciones significativas en
relación con la desnutrición.
Conclusión: Al analizar la variable IMC, la cual se
agrupó en desnutridos y no desnutridos (que incluyó peso normal, sobrepeso y
obesidad), el grupo de desnutridos (según el IMC) tuvo 5.5 veces más riesgo de
presentar desnutrición que el grupo de no desnutridos. Al analizar la variable
niveles de albúmina, la cual se agrupó en valor normal y valor disminuido, el
grupo de valor disminuido de albúmina tuvo 3.6 veces más riesgo de presentar
desnutrición que el grupo de valor normal de albúmina. Resulta necesaria una
valoración adecuada del estado nutricional al ingreso del paciente al servicio
de terapia Intensiva para definir e identificar aquella población de riesgo e
iniciar un programa nutricional precoz y oportuno.


LC Perez Illidge(1),
L Aguirre(2), G Tuhay(2), N Peña(2), ML Ojeda(2), S Finoli(2), M Acebo(2), E
Giordanino(2), R Pantoja(2), F Klein(2)
(1) Favaloro. (2) Fundacion Favaloro.
Introducción: Los receptores de trasplantes de órganos
sólidos pueden tener un mayor riesgo de COVID-19 por la inmunosupresión.
Métodos: Analizamos una cohorte retrospectiva desde
julio del 2020 a julio 2022 en pacientes internados en terapia intensiva con
Neumonía severa (NS) por SARS-COV-2 portadores de Trasplante de Órgano Solido
(TOS), usando SPSS v26.0 para el analisis estadistico.
Resultados: Veintiséis pacientes con TOS fueron internados
en terapia intensiva con NS entre julio del 2020 a julio del 2022. La variables
demográficas y clínicas son presentadas en la tabla 1. Todos los pacientes
fueron tratados con dexametasona según protocolo RECOVERY y medidas de soporte.
Se encontró una mortalidad del 47%, asociada principalmente por hipoxemia
refractaria en 8/12(66.7%), encontrándose insuficiencia renal aguda (IRA) en
15/26(57.7%), de los cuales 8/15(53.3%) requirieron Terapia de Reemplazo Renal.
En el análisis univariable la IRA (P:0.034), el requerimiento de Asistencia
ventilatoria mecánica (P:0.0001), el Distress respiratorio (P:0.005), la
fibrosis pulmonar (P:0.0001) y la sobreinfección pulmonar (P:0.005); esta
última relacionada con infección por aspergilosis pulmonar 5/26(19%), fueron
asociadas a mortalidad. Ni la vacunación o el tipo de trasplante tuvieron una
asociación estadística significativa (P:0.249 y P:0.554). En el análisis
multivariable por regresión logística la sobreinfección se presentó como
predictor independiente de mortalidad.(Tabla2)
Discusión: El COVID19 está relacionado con alta
morbimortalidad en los TOS, siendo incierto el rol de la vacunación, al igual
que los diferentes esquemas de inmunosupresión de mantenimiento en estos
pacientes. En nuestra cohorte la hipoxemia refractaria secundaria a fibrosis
pulmonar, fue la causa principal de muerte, con una proporción alta de
sobreinfección fúngica.
Conclusión: La mortalidad asociada a COVID 19 en nuestra
cohorte está directamente relacionada con la evolución de la injuria pulmonar.
Terapéuticas dirigidas al control de la inflamación e injuria pulmonar podrían
mejorar el outcome de estos pacientes. Además dedemos tener en cuenta la
terapia antifúngica empírica en los episodios con sospecha de sobreinfección
pulmonar, dado la frecuencia de arpergilosis encontrada.


F Scarselletta(1), L
González(1), C Rios(1), S Lucini(1), C Sfara(1), N Díaz(1), L Zubeldía
Brenner(1), G Vinicoff(1), J Farina(1), S Esposto(1), F Gil(1)
(1) Hospital De Alta Complejidad Cuenca Alta
Néstor Kirchner.
Introducción: Los programas de optimización de
antimicrobianos (PROA) mejoran resultados clínicos y minimizan efectos
adversos, emergencia de resistencia y gasto por uso inadecuado.
Objetivos: Evaluar apropiabilidad de antimicrobianos en
pacientes de terapia intensiva, las intervenciones farmacéuticas (IF) y su
aceptación por parte del equipo médico dentro del PROA.
Métodos: Estudio observacional, prospectivo, mediante
cortes semanales sobre prescripciones de antimicrobianos de pacientes en UTI.
Se registró: antimicrobiano, tipo de tratamiento, IF por motivo y aceptación.
Se evaluó apropiabilidad según indicación, posología, duración y antimicrobiano
en pase semanal entre bacteriología, infectología y farmacia, basada en
protocolos locales y criterio clínico-bacteriológico.
Resultados: Se obtuvieron 24 cortes con 365 indicaciones.
Apropiabilidad global 88%. Los motivos de inadecuación fueron: no indicación
22, antimicrobiano inadecuado 12, duración 5, posología 4. Por tipo de
tratamiento, resultaron inadecuados: 34 de 193 empíricos, 6 de 145 dirigidos y
3 de 16 dirigidos por gram. Las 11 profilaxis médicas fueron apropiadas.
Antimicrobianos más indicados: colistin,
vancomicina, meropenem, ampicilina-sulbactam y piperacilina-tazobactam.
Antimicrobianos más inadecuados: vancomicina, colistin, meropenem y
piperacilina-tazobactam.
De 365 prescripciones 181 tuvieron IF con 96%
aceptadas. De 320 adecuados 160 sufrieron optimizaciones farmacoterapéuticas
incrementando la apropiabilidad. De los inadecuados fueron intervenidos y no
aceptados 4. Las IF por motivo fueron: posología 119, administración 57,
antimicrobiano 17, evento adverso 12, monitoreo 6, vía de administración 4,
indicación 3 y 8 sin datos.
Conclusiones: La apropiabilidad superó el 85% promedio. De
las prescripciones inadecuadas, la elevada proporción por no indicación
evidencia su uso no racional. La elección incorrecta de antimicrobianos
empíricos demuestra falta de claridad del foco infeccioso en pacientes críticos
y la urgencia en su prescripción.
Los antimicrobianos más indicados y más
inadecuados coinciden con los protocolizados como empíricos según flora local.
Las IF aumentaron la apropiabilidad con
amplia optimización de posología, reflejado en el alto porcentaje de IF y bajo
de no apropiabilidad por tal motivo. La gran aceptación de IF se relaciona con
la consolidación del farmacéutico clínico dentro del equipo de UTI.
Como limitante se destaca el subregistro de
IF. Del análisis se visualizan oportunidades de mejora y prioridades de
abordaje: mejorar la prescripción de tratamientos empíricos y elección del
esquema.


0407 Síndrome de
hiperestimulación ovárica, a propósito de un caso
D Carpio(1), DI
Carpio Celis(1), M Chavez(1), J Ortiz(1)
(1) Hospital De Clinicas Jose De San Martin.
Introducción: El síndrome de hiperestimulación ovárico
(OHSS) es una complicación iatrogénica durante los ciclos de reproducción
asistida (ART), la incidencia en casos moderados se estima entre el 3 y el 6% y
su forma grave del 0,1-3%. El diagnóstico precoz y el conocimiento de los
mecanismos fisiopatológicos de sus manifestaciones clínicas permite el manejo
adecuado sus complicaciones.
Se presenta el caso de una mujer de 25 años
multípara, tratada con agonistas GnRH, donante de óvulos desde 1 año previo. La
paciente ingresa a terapia intensiva con diagnóstico OHSS grave, post
aspiración manual endouterina por embarazo de 5 semanas. Al examen inicial
estaba consciente, vía área expedita y sin vasoactivos. Abdomen distendido,
blando, doloroso a la palpación profunda en hipogastrio, sin defensa ni
reacción peritoneal. Presión intraabdominal (PIA) 11 mmHg, diuresis 0.6
ml/kg/h. Leucocitosis, hiponatremia hipoosmolar con LEC aumentado. Ecografía:
Liquido libre en fondo de saco de Douglas y espacio de Morrison. Ovario derecho
12 cm, no se observa derrame pleural. VCI índice de colapsabilidad < 50%. 48
horas después deteriora ritmo diurético (diuresis 0.3 ml/kg/h), PIA: 14 mmHg;
presión de perfusión renal (PPR): 65 mmHg. Paracentesis evacuatoria: 5 Litros
de líquido citrino, GASA.
Discusión: La valoración del OHSS por la escala de
Colegio real de Obstetras y Ginecólogos (RCOG) puso en evidencia la verdadera
gravedad de esta paciente. Si bien la oliguria mejoro después de evacuar la
ascitis, la medición de la PIA fue de rango moderado. La detección del colapso
de la VCI permitió reconocer a la hipovolemia como parte importante del
mecanismo de oliguria
Conclusión: La utilización de scores objetivos de
gravedad, la medición de la presión intraabdominal y la ecografía para la
valoración de la volemia son herramientas fundamentales para el tratamiento
adecuado de la forma grave de este síndrome.
0408 FALLA MULTIORGANICA DE ETIOLOGIA POCO
FRECUENTE
MA Misa(1), DC
Rodriguez(1), CL Landoni(1), A Brañez Toro Yasmani(1), A Luzzi(1), C Plaza(1),
S Markevich(1), S Roldan Montaño(1), J Vazquez(1), A Brizuela(1), JP Soliz(1)
(1) Sanatorio Julio Mendez.
Introducción: Se presenta el caso de una paciente que
evoluciono con falla multiorganica posteriormente a una cirugia de cadera, se
descarto shock hemorragico evidenciandose hemolisis en contexto de paciente con
antecedentes de drepanocitosis.
Presentación del caso: Paciente femenina de 54 años de edad, con
antecedentes de necrosis aséptica de
cabeza de fémur izquierda y anemia
drepanocítica + betatalasemia. Ingresa de forma programada para artroplastia de
cadera derecha por necrosis avascular de fémur derecho. A las 6 hs posoperaotia
presenta anemia aguda, oliguria, insuficiencia renal aguda AKI II, acidosis
metabólica, alteración del sensorio y falla hepatica aguda. Se inicia
resucitación con cristaloides, 2 UGR, 1 plasma fresco sin mejoría, con nueva
caida del hto, sin evidencia de sangrado. Al no encontrarse signos evidentes de
sangrado se solicita imagen tomográfica: TÓRAX: múltiples infiltrados en vidrio
esmerilado bilateral con tendencia a la consolidación. ABDOMEN: Escaso líquido
libre laminar subhepático. Se observa en laboratorio parametros de hemolisis y
se diagnostican crisis drepanocítica con fallo multiorgánico. Se decide
realizar eritroaféresis, con posterior mejoria de falla renal y hepatica.
Evoluciona 48 horas después con insuficiencia ventilatoria y progresion de
infiltrados pulmonares, que la lleva a asistencia respiratoria mecánica, asocia
a descompensación hemodinámica con requerimiento vasopresor y transfusión de
glóbulos rojos. Valorada por servicio de hematología, sin requerimiento de
nueva eritroaferesis, inicia tratamiento con EPO e hidroxiurea.
Discusión: La HbS, resultante de la mutación en el gen
que codifica la subunidad beta de la hemoglobina, tiende a polimerizarse con la
desoxigenación, quedando como resultado un hematíe con forma de hoz, rígido.
Dichos hematíes deformados no pueden atravesar la microcirculación de forma
normal, produciendo un aumento de la viscosidad sanguínea, que conduce a la
formación de microtrombos y a la oclusión de los pequeños vasos, dando lugar a
las crisis vaso-oclusivas, que son el paradigma de esta enfermedad. Las
manifestaciones clínicas son muy variadas y pueden afectar a multitud de
órganos. La más característica es la crisis de dolor vaso-oclusiva, sin
embargo, dado que el mecanismo fisiopatológico es la vaso-oclusión y posterior
isquemia tisular, se puede producir daño en la mayoría de los órganos, pudiendo
llevar a la falla multiorganica.
M Isa(1)
(1) Clinica Regional Del Sud.
Introducción: Mostrar la utilidad de la información
aportada por la ultrasonografía transesofágica de lo que está sucediendo en
forma dinámica en la interaccion corazon-pulmon durante la maniobra de
reclutamineto alveolar
Reporte Caso Clínico: Mujer 32 años. APP: epilepsia. MI: status
epileptico - neumonía grave de la comunidad. Ingresa a UTI con GSC 7, se
realiza intubación orotraqueal, se conecta al respirador. Inestable
hemodinámicamente, con utilización de drogas vasoactivas. Ex Físico: marcada
hipoventilación en campo pulmonar izq. roncus generalizados. Sat 02 86% c/Fio2
100%.
Procedimiento: Colocamos la ste a nivel medioesofagico, 30
cm de la arcada dentaria, con el multiplanar 0-20° vista apical 4 cámaras,
valoración visual inicial, determinando E/A, doppler tisular, E/e´.
Luego nos para valorar pulmon en esofago
medio, tomando como referencia a la vena pulmonar superior izquierda; para eso
nos posicionamos con el multiplanar 60-70° en 2 cámaras, apareciendo por encima
de la orejuela izquierda. Giramos en sentido horario-antihorario, para examinar
pulmón derecho e izquierdo respectivamente.
Evaluación visual: Conserva la relación ⅔ - ⅓.
Las paredes del Ventrículo izquierdo se
acercan bien entre sí.
Valva anterior de Válvula mitral
prácticamente toca el septum interventricular. Sin derrame pericárdico.
Determinamos en pulmón izquierdo, a nivel de
esofago medio la presencia de imagen de consolidación pulmonar, compatible con
neumonía.
Cambio Fraccional de Área de Ventrículo
Derecho:
El cambio fraccional de área del ventrículo
derecho, es similar al área de cambio fraccional del VI , y también sirve como
una medida sustituta de la fracción de eyección del ventrículo derecho.
La evaluación del Cambio Fraccional de Área
de ventrículo derecho se realiza a nivel medio esofágico, en la vista de cuatro
cámaras
Es el cambio porcentual en el área
ventricular entre sístole y diástole con un valor normal >35 %. Mientras que
CFA<35 % indica disfunción, los valores inferiores al 17 % son sugestivos de
disfunción grave del VD.
Neumonía grave adquirida de la comunidad.
pulmón izquierdo
Paciente en asistencia respiratoria mecánica,
ante la falta de respuesta al tratamiento, se decide realizar maniobras de
reclutamiento alveolar. Se realizan bloqueantes neuromusculares, medimos vena
cava inferior, estimación de presión de aurícula derecha.
Monitorizando con la sonda transesofágica el
comportamiento del estado CV, y el estado de ambos pulmones a medida que se
realizaba dicha maniobra.
Procedimiento: Asistencia respiratoria mecánica:
incrementamos peep de 5 en 5 hasta llegar a 30 cm, o al alcanzar el límite de
presión máxima, o caída de Sat O2, o inestabilidad hemodinámica.Se evaluó
función CV: E/A, doppler tisular. CFA y evaluación volumétrica de
VD.Colapsabilidad de VCS.
Resultado: Pudimos valorar con la sonda transesofágica
en forma dinámica, con ligeros movimientos de rotación en sentido
horario/antihorario los cambios en pulmón, de patrón de consolidación con
broncograma aéreo dinámico, a un patrón de líneas A-B. Con SatO2 que fue de 88%
a 98%. Logrando establecer el nivel de PEEP óptimo en 12 cm. sin caída de SatO2
Asimismo pudimos evaluar constantemente la
función cardiovascular, sin deterioro de la misma tanto en cavidades derechas;
determinando en cada maniobra realizada el CFA de ventrículo derecho como
izquierdas. Sin compromiso hemodinámico.
Se trató de un procedimiento seguro, y sin
complicaciones.
Al cabo de 72 hs se comenzó con maniobras de
weaning, guiado por ultrasonografía, pudiendo ser extubada con éxito.

0410 Acidosis piroglutámica con
GAP elevado asociado a consumo de paracetamol
MB Pollian(1), M
Cuestas Rios(1), F Loiacono(1), J Sagardia(1), N Balderrama(1)
(1) Nacional Prof. A. Posadas.
Introducción: La acidosis metabólica con brecha aniónica
alta es una alteración acidobásica común que se encuentra en pacientes
hospitalizados por acumulación de lactato, cetonas, urea y la ingestión de
toxinas. Sin embargo, en los casos en que no se encuentre otra explicación, se
deben sospechar etiologías menos frecuentes como acumulación ácido
piroglutámico (PGA) la cual se ha asociado con el uso crónico de paracetamol.
Presentación: Se presenta caso clinica de una paciente
femenina de 66 años de edad antecedentes de hipertension arterial,
insuficiencia renal cronica, diabetes insulino requiriente. Quien consulta a
guardia de nuestro hospital por cuadro de una semana de evolucion caracterizado
por disuria, hematuria, dolor abdominal, constipacion. Al interrogatorio
dirigido refiere consumo de 1gr de paracetamol diario por mas de 10 dias debido
a dolor lumbar.
Se realiza laboratorio evidenciando PH 6.9,
bicarbonato 3.4 y anion gap de 19. Se descartan causas obstructivas, acidosis
por glicoles, l-lactato, methanol, aspirina, cetonas, sin embargo en contexto
de insuficiencia renal cronica, acidosis metabolica severa con gap aumentado y
consumo de paracetamol, se llega al diagnostico de acidosis piroglutámica.
Discusión: La acidosis piroglutámica es una causa raramente
reconocida aunque es probable que esté infradiagnosticada dada la alta
prevalencia de factores de riesgo. Estos incluyen edad avanzada, sepsis,
desnutrición, diabetes no controlada, género femenino, enfermedad hepática
crónica, enfermedad renal crónica y uso de paracetamol.
Conclusión: El manejo inadecuado de los trastornos
metabólicos puede ser un factor que contribuya a la morbilidad y mortalidad de
los pacientes, lo cual es importante reconocer y fácil de manejar. Por lo
tanto, el reconocimiento y manejo adecuado de la acidemia piroglutámica podría
beneficiar a los pacientes con factores de riesgo para su desarrollo asi como
el manejo multidisciplinario del mismo.
ÍNDICE DE AUTORES
|
Autor |
Resumen |
|
|
|
|
A |
|
|
276 |
|
|
358 |
|
|
372 |
|
|
176 |
|
|
177 |
|
|
149 |
|
|
368 |
|
|
170 |
|
|
346 |
|
|
289 |
|
|
369 |
|
|
57 |
|
|
275 |
|
|
141 |
|
|
381 |
|
|
395 |
|
|
51 |
|
|
286 |
|
|
53 |
|
|
26 |
|
|
305 |
|
|
76 |
|
|
336 |
|
|
|
|
|
B |
|
|
215 |
|
|
182 |
|
|
299 |
|
|
379 |
|
|
179 |
|
|
362 |
|
|
123 |
|
|
79 |
|
|
342 |
|
|
189 |
|
|
162 |
|
|
183 |
|
|
52 |
|
|
374 |
|
|
18 |
|
|
152 |
|
|
352 |
|
|
218 |
|
|
232 |
|
|
25 |
|
|
32 |
|
|
19 |
|
|
323 |
|
|
272 |
|
|
|
|
|
C |
|
|
324 |
|
|
58 |
|
|
205 |
|
|
186 |
|
|
20 |
|
|
221 |
|
|
197 |
|
|
67 |
|
|
407 |
|
|
252 |
|
|
392 |
|
|
47 |
|
|
384 |
|
|
41 |
|
|
235 |
|
|
101 |
|
|
178 |
|
|
300 |
|
|
301 |
|
|
302 |
|
|
327 |
|
|
223 |
|
|
329 |
|
|
115 |
|
|
398 |
|
|
104 |
|
|
111 |
|
|
338 |
|
|
290 |
|
|
298 |
|
|
116 |
|
|
124 |
|
|
125 |
|
|
129 |
|
|
331 |
|
|
103 |
|
|
265 |
|
|
148 |
|
|
184 |
|
|
279 |
|
|
|
|
|
D |
|
|
202 |
|
|
27 |
|
|
307 |
|
|
312 |
|
|
93 |
|
|
50 |
|
|
318 |
|
|
80 |
|
|
81 |
|
|
135 |
|
|
335 |
|
|
108 |
|
|
131 |
|
|
38 |
|
|
39 |
|
|
82 |
|
|
|
|
|
E |
|
|
98 |
|
|
325 |
|
|
311 |
|
|
|
|
|
F |
|
|
110 |
|
|
377 |
|
|
349 |
|
|
350 |
|
|
195 |
|
|
284 |
|
|
99 |
|
|
320 |
|
|
326 |
|
|
1 |
|
|
55 |
|
|
220 |
|
|
297 |
|
|
231 |
|
|
|
|
|
G |
|
|
180 |
|
|
245 |
|
|
249 |
|
|
229 |
|
|
383 |
|
|
386 |
|
|
246 |
|
|
400 |
|
|
263 |
|
|
159 |
|
|
89 |
|
|
112 |
|
|
294 |
|
|
268 |
|
|
330 |
|
|
139 |
|
|
190 |
|
|
36 |
|
|
45 |
|
|
65 |
|
|
87 |
|
|
166 |
|
|
261 |
|
|
340 |
|
|
119 |
|
|
200 |
|
|
107 |
|
|
295 |
|
|
247 |
|
|
128 |
|
|
23 |
|
|
270 |
|
|
198 |
|
|
154 |
|
|
269 |
|
|
171 |
|
|
157 |
|
|
158 |
|
|
206 |
|
|
283 |
|
|
334 |
|
|
132 |
|
|
69 |
|
|
11 |
|
|
|
|
|
H |
|
|
360 |
|
|
21 |
|
|
185 |
|
|
|
|
|
I |
|
|
256 |
|
|
250 |
|
|
359 |
|
|
409 |
|
|
228 |
|
|
|
|
|
J |
|
|
134 |
|
|
396 |
|
|
49 |
|
|
|
|
|
K |
|
|
105 |
|
|
328 |
|
|
306 |
|
|
|
|
|
L |
|
|
54 |
|
|
281 |
|
|
60 |
|
|
46 |
|
|
31 |
|
|
|
|
|
M |
|
|
48 |
|
|
28 |
|
|
29 |
|
|
210 |
|
|
199 |
|
|
207 |
|
|
370 |
|
|
12 |
|
|
14 |
|
|
367 |
|
|
277 |
|
|
44 |
|
|
153 |
|
|
332 |
|
|
127 |
|
|
9 |
|
|
192 |
|
|
385 |
|
|
380 |
|
|
165 |
|
|
62 |
|
|
402 |
|
|
408 |
|
|
339 |
|
|
213 |
|
|
121 |
|
|
30 |
|
|
315 |
|
|
35 |
|
|
227 |
|
|
144 |
|
|
274 |
|
|
230 |
|
|
161 |
|
|
10 |
|
|
|
|
|
N |
|
|
164 |
|
|
|
|
|
O |
|
|
321 |
|
|
130 |
|
|
356 |
|
|
314 |
|
|
109 |
|
|
363 |
|
|
|
|
|
P |
|
|
168 |
|
|
8 |
|
|
240 |
|
|
376 |
|
|
212 |
|
|
174 |
|
|
264 |
|
|
388 |
|
|
224 |
|
|
394 |
|
|
404 |
|
|
397 |
|
|
355 |
|
|
237 |
|
|
96 |
|
|
389 |
|
|
260 |
|
|
34 |
|
|
163 |
|
|
259 |
|
|
145 |
|
|
410 |
|
|
304 |
|
|
72 |
|
|
285 |
|
|
|
|
|
Q |
|
|
94 |
|
|
296 |
|
|
317 |
|
|
319 |
|
|
|
|
|
R |
|
|
211 |
|
|
214 |
|
|
118 |
|
|
120 |
|
|
239 |
|
|
42 |
|
|
77 |
|
|
70 |
|
|
156 |
|
|
391 |
|
|
61 |
|
|
83 |
|
|
84 |
|
|
85 |
|
|
344 |
|
|
140 |
|
|
241 |
|
|
378 |
|
|
24 |
|
|
345 |
|
|
266 |
|
|
188 |
|
|
6 |
|
|
|
|
|
S |
|
|
102 |
|
|
293 |
|
|
353 |
|
|
133 |
|
|
278 |
|
|
88 |
|
|
405 |
|
|
169 |
|
|
181 |
|
|
113 |
|
|
2 |
|
|
3 |
|
|
151 |
|
|
333 |
|
|
347 |
|
|
354 |
|
|
364 |
|
|
393 |
|
|
403 |
|
|
78 |
|
|
226 |
|
|
365 |
|
|
248 |
|
|
|
|
|
T |
|
|
187 |
|
|
155 |
|
|
401 |
|
|
288 |
|
|
280 |
|
|
|
|
|
U |
|
|
74 |
|
|
|
|
|
V |
|
|
97 |
|
|
117 |
|
|
59 |
|
|
225 |
|
|
242 |
|
|
251 |
|
|
75 |
|
|
100 |
|
|
40 |
|
|
73 |
|
|
15 |
|
|
282 |
|
|
71 |
|
|
351 |
|
|
375 |
|
|
63 |
|
|
64 |
|
|
|
|
|
W |
|
|
136 |
|
|
138 |
|
|
|
|
|
Y |
|
|
216 |
|
|
|
|
|
Z |
|
|
17 |
|
|
90 |
|
|
217 |
|
|
234 |